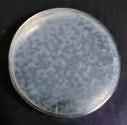
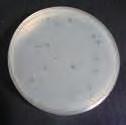

CATALOG GUIDE カタログご利用のご案内
■スペックの見方

■商品の価格について
商品番号
商品名 メーカー希望 小売価格 (税抜価格)
オフィスチェア 価格(税抜)サイズ(mm)梱包才数梱包重量
K-921 27,600円 W440×D570×H800~930 (SH425~555) 4.2才12.3kg
仕様/張地:布 脚:エンプラ樹脂成型品 (ブラック) 背:モ-ルドウレタン 入数:1
●座昇降 (ガスシリンダ-式) 機能付 ●背ロッキング機構付 ●背スウィング機能付
本文中の表示価格は令和5年12月現在のものです。予告なく 変更する場合がございますのであらかじめご了承ください。
■商品の仕様について
本文中の商品仕様は令和5年12月現在のものです。諸般の 事情および品質改良のため、予告なく変更・中止することがあ ります。
■商品の色調について
各商品の色調は生産時の気温、湿度等々により、ロットによっ て若干異なる可能性があります。あらかじめご了承ください。
仕様
■商品の納期について 商品の納期につきましてはご確認のうえ、ご発注ください。
■印刷の色調について
各商品の写真は、印刷によって実際の色彩と多少異なる場合 がございます。あらかじめご了承ください。
本カタログ掲載商品は全アイテム、生産物賠償責任保険(PL保険)に加入しています。
K-921(BL)

完成品
新製品及び新色追加製品
難燃試験に合格した張地を 使用しています。
防臭加工を施してあります。
防カビ加工を施してあります。
実用十分なアルコール耐性を 持たせた張地です。
環境ホルモン(外因性内分泌 撹乱化学物質)の疑いがある フタル酸エステル系可塑剤を 使用していない張地です。
“鉛、水銀、カドミウム、六価 ロム、ポリ臭化ビフェニール、 ポリ臭化ジフェニルエーテル”を 使用していない張地です。
光触媒による環境浄化作用があります。
マグネットの使用が可能な製品です。
張地に合成皮革を 使用した製品です。
サイズや色などを お好みの仕様で別注 対応可能な製品です。
完成品 (一部組み立てが必要)
組み立てが必要な製品
グリーン購入法適合商品 国産製品
防炎加工を施してあります。
消臭作用があります。
抗菌作用があります。
アルコール系薬剤の メンテナンスに強い張地です。
薬品に対し、硬化しにくく、 風合いを持続させます。
RoHS指令に適合した張地を 使用した製品です。
特殊表面加工により汚れが付きにくく、 拭き取りやすくなっています。 乾拭きで落ちない場合、中性洗剤を 加えた水で拭き取ってください。
遮光性のある生地を 使用した製品です。
張地に布を使用 した製品です。
抗ウイルス作用のある SIAA登録製品です。
汚れが付きにくく、落としやすい 加工を施してあります。
防腐処理を施してあります。
抗ウイルス作用があります。
濃度1000ppm以下の 次亜塩素酸で拭いて除菌が できます。
油に対し、硬化しにくく、 風合いを持続させます。
ホルムアルデヒドの放散量が 少ない材料を使用しています。
ピンナップの使用が可能な製品です。
丸洗いができる生地を 使用した製品です。
お好みの張地に 替える別張対応が 可能な製品です。
抗菌作用がある SIAA登録製品です。





エッジ部分に 抗ウイルスコーティングを 施してあります。
背もたれのみが後ろに 傾斜する機構です。
背もたれが使用者に 追従して左右に可動する 機構です。
背もたれを特定の位置で 固定することが可能です。
背もたれの材質にモールド ウレタンを使用しています。
座面にかかる体圧を 分散して疲労を軽減させる 性能があります。
アームレスト(肘掛部)が前後に スライド可動します。
上方向に積み重ねて収納が可能です。
折り畳んだ状態で上方向に積み 重ねて収納することが可能です。
クランク式の脚機構を採用した 折畳会議テーブルです。
■色表示について
背・座全体が一体で後ろに 傾斜する機構です。
背もたれの奥行を調整する ことが可能です。
ガスシリンダーにより座面の 高さ調節が可能です。
座面の材質にモールド ウレタンを使用しています。
背もたれにランバーサポートが 付いており、適正な着座姿勢を維持します。
アームレスト(肘掛部)が左右に 回転可動します。
ショッピングカートのように前後 方向に収納することが可能です。
主に外観が天然木や成型 合板を使用したチェアです。
スプリングの張力を利用した脚機構の 折畳会議テーブルです。
背もたれと座が2:1の割合で 独立しつつ同調(シンクロ)して 後ろに傾斜する機構です。
背もたれの高さを調整 することが可能です。
座面の奥行を調整する ことが可能です。
座面の材質にウェービング テープを使用しています。
アームレスト(肘掛部)が上下に 昇降可動します。
ヘッドレストの取付が可能です。
折り畳んでの運搬や収納が可能です。
スライド式の脚機構を採用した 折畳会議テーブルです。
AK :オーク DBR :ダークブラウン HWH :ヒッコリーホワイト LYE :ライトイエロー RD :レッド AQ :アクア DGN :ダークグリーン IV :アイボリー MAK :ミディアムオーク RO :ローズ BE :ベージュ DGR :ダークグレー LBL :ライトブルー MP :メープル SGR :ストーングレー BJ :ベージュ DRD :エンジ LBR :ライトブラウン MS :マスタード SV :シルバー BK :ブラック GJ :グレージュ LGN :ライトグリーン NA :ナチュラル TE :チーク BL :ブルー GL :ゴールド LGR :ライトグレー NS :梨地 TQ :ターコイズ BR :ブラウン GL :グレー LIV :ライトアイボリー NV :ネイビー WH :ホワイト
CGR :チャコールグレー GN :グリーン LM :ライム OL :オリーブ WN :ワイン
CH :チェリー GR :グリーン LPK :ライトピンク OR :オレンジ WN :ウォールナット
CR :クリア GR :グレー LSV :ライトシルバー PK :ピンク WT
:ウォールナット DBL :ダークブルー HBR :ハニーブラウン LWT :ライトウォールナット PR :パープル YE :イエロー
■マークについて
抗ウイルス製品
抗ウイルス製品について
弊社抗ウイルス製品は、病院・学校(幼・保育園)・老健施設・店舗・オフィスなど様々な生活空間に安心感を与えるべく 抗菌・抗ウイルス性能の向上を目指した製品です。
抗菌・抗ウイルス性能を持つメラミン化粧板を使用したSIAA登録製品、抗ウイルス壁紙を採用した製品、テーブルのエッ ジまで抗ウイルス化にこだわり、ウイルスの感染経路への予防対策としてお奨めできる製品となっています。
弊社製品に使われている抗菌・抗ウイルス材料
■表面材
抗菌・抗ウイルス メラミン化粧板(テーブル・パーティション等)
■エッジ材
抗ウイルス ソフトエッジ(テーブル)
抗ウイルス ABSエッジ(テーブル・シェルフ等)
SIAA登録製品 テーブル・天板・棚板等
■裏面材
抗ウイルス バッカー(テーブル・シェルフ等)
パーティション等
ソフトエッジ(自社開発)
SIAA(抗菌製品技術協議会)とは
ABSエッジ


【ご注意】
・SIAAの安全性基準に適合しています。
・抗ウイルス加工は、病気の治療や予防を目的とするものではありません。
・本製品は感染予防を保証するものではありません。




特殊な抗ウイルスコーティングを 施してあります。
適正で安心できる抗菌・防カビ・抗ウイルス加工製品の普及を目的とし、抗菌剤・防カビ剤・抗ウイルス剤および抗菌・防 カビ・抗ウイルス加工製品のメーカー、試験機関が集まってできた団体です。
・抗ウイルス性能は全てのウイルスに対して発現するものではありません。また、全てのウイルスに同様の試験結果が 得られるとは限りません。
・試験機関での結果であり、実際の使用状況で同様の効果を保証するものではありません。
・医薬品や医療機関などの医療を目的とした製品ではありません。
・表面のツヤが変化するほど摩耗すると抗ウイルス性能が低下する事があります。
・表面に汚れなどが付着した状態では、効果を発揮する事ができませんので、適切なお手入れを実施してください。
068002
抗ウイルスメラミン化粧板
このメラミン化粧板は食品施設、病院、老健施設、学校(幼・保育園)などの衛生空間に安心感を与える、業界初の抗ウ イルス機能を持つ化粧板です。
社内抗ファージウイルス試験結果による目で見える効果
SOCIA抗ウイルスチェアデスク
一般メラミン化粧板と比較し、時間の経過と共に、目に見えて効果を感じることができます。
0時間後
抗ウイルス
メラミン化粧板

1時間後 15分後


ウイルスが減少。
8時間後

試験機関による数値で見える効果 ※下記データは測定値であり保証値ではありません。
一般メラミン化粧板と比較し、24時間後に99%以上減少の抗ウイルス、抗菌効果を達成。 光触媒ではない為、室内の明るさ暗さに関係なく抗ウイルス、抗菌効果を発揮します。
テーブル応接ロビー
薬事法の関係上、特定のウイルス名は表記しておりません。
耐久性・即効性・耐薬品性について
※下記データは測定値であり保証値ではありません。
水拭き機械にて、 36,500回 の拭き取り試 験を行っても抗ウイルス機能は低下せず、 99%減少したという試験結果があります。 通常は中性洗剤での拭き掃除を推奨します が、 0.05%に希釈した『 次亜塩素酸ナトリ ウム 』で拭き掃除を行っても、抗ウイルス の性能は低下することなく、メラミン化粧板 表面の劣化もありません。
木工福祉幼保
注意事項
1 アルカリ性洗剤、酸性洗剤、及び塩素系成分を含む洗剤を 使用すると、化粧面が変色・劣化する場合があります。
2 抗ウイルス剤は表面付近に付着させているため、表面が削れ たり、傷ついたりすると抗ウイルス性能は低下します。
レンタル リース 抗ウイルス
エクス テリア
オフィス アクセサリー
パーティ
·
ション
069 抗ウイルスファニチャー 003
抗ウイルスガラスコーティング
抗ウイルス・抗菌効果 メカニズム
SOCIA抗ウイルスチェアデスク
① ガラス膜と一体化した抗ウイルス・抗菌成分が、空気中の 気体成分(O₂、H₂Oなど)を活性化させて細胞膜を攻撃する ラジカルへ変換する。
② ①で発生した活性化ラジカルが、ウイルスや菌の 外壁を攻撃し、破壊する。
抗ウイルス
③ ウイルスや菌が不活性化(=死滅)し、感染リスクを 減少させる。
ガラスコーティングの機能
ガラス表面は、耐汚染性を有しています。有機系塗料と比較して表面劣化はほとんどないため、 汚れの拭き取りも容易です。
基材表面にガラス層を形成しますので、水分の浸透がなく高い撥水性を有します。
ガラスコーティング層は石英ガラスと同等です。促進耐候性試験では5年分を照射した後でも、 コーティング層が残っていることを確認しています。
ガラスコーティング表面の硬度は9H相当でメラミン化粧板が6H~7H相当ですから、より強靭 で防傷・耐摩耗性も向上します。
※コーティング層は0.1㎛程度で非常に薄いため、下地素材の影響を大きく受けます。金属とプラスチック或いは、木質など素材の違いで防傷 性能は変化します。
ガラスコーティング層は薬品や有機溶剤に侵されることがなく、消毒の次亜塩素酸などの薬品 やシンナーからも基材表面を保護します。マジックペンなどの落としにくい油性に対しても 塗装用シンナーで落とすことが可能です。
※ 強アルカリ洗剤の使用はできません。
イスの肘や取手、操作レバーなど、人の手が触れる場所の多い製品などに
VFTRシリーズ
ガラスコーティングを施すことで、抗ウイルス製品にすることが可能です。
通常品
通常品


ガラスコーティング
天板は共通 抗ウイルスメラミン
ガラスコーティング 通常品にガラスコーティングを 施すことでALL抗ウイルス製品に することが可能です。
木工福祉幼保

別途見積り
※別途見積り
レバー
調整ノブ
キャスターロック
抗ウイルス福祉用テーブル価格(税抜価格)サイズ(W×D×H)(mm) 梱包才数梱包重量 VFTR-1890N(NA)
VFTR-1690N(NA)
VFTR-1590N(NA)
VFTR-1290N(NA)
仕様/天板:抗ウイルスメラミン化粧板(28mm厚) 抗ウイルスソフトエッジ巻 天板裏:抗ウイルスバッカー 脚: スチール(φ50.8mm) 粉体塗装 入数:1



脚のみ ガラスコーティング 087
グリップ/ ブレーキレバー 肘掛
ハンドリム
004
· パーティ ション
エクス テリア オフィス アクセサリー
テーブル応接ロビー
レンタル リース
1800×900×700 ▲ 6.2才23kg
1600×900×700 ▲ 5.5才20kg
1500×900×700 ▲ 5.3才17kg
1200×900×700 ▲ 4.3才15kg
VWST-9055
VWST-9055
ハンドブレーキ WE-K1 WE-K1
SOCIA

ASO-CT1845B/W P.046 カウンターテーブル

ASO-WT6045B P.049 ワークテーブル
チェア

ALES-P- □ - □ -B P.056 チェアパッド付黒塗装脚

ASO-CT1845M B/W P.046 カウンターテーブル(幕板付)

ASO-ST400B P.049 サイドテーブル

ASO-WC1 P.052 木製チェア

ASO-CTB P.057 カウンターチェア

ASO-W1111B/W P.042 ワークテーブル

ASO-HCT1845B/W P.046 カウンターテーブル

ASO-ST4540B P.049 サイドテーブル

ASO-WC1(別張り) P.052 NEW 木製チェア

ASO-HC320W P.057 ハイチェア

ASO-W1811B/W P.042 ワークテーブル

ASO-HCT1845M B/W P.046 カウンターテーブル(幕板付)

ASO-WD6050B P.049 ワークデスク

ASO-WC2T P.053 木製チェア

ASO-HC320C P.057 ハイチェア

ASO-W2411B/W P.042 ワークテーブル

ASO-CF750B/W P.047 カフェテーブル


ASO-WH1811B/W P.043 ワークテーブル

ASO-CF7575B/W P.047 カフェテーブル

ASO-PT1790 P.050 プランターテーブル ASO-PT1271KH P.050 プランター片面ハイテーブル



ASO-DT1290B P.044 ミーティングテーブル

ASO-CF1260B/W P.048 カフェテーブル

ASO-PT1211RH P.050 プランター両面ハイテーブル

ASO-WC2F-NA P.053 木製チェア CKH11 P.054 オフィスチェア メッシュ張り CKH11-AR P.054 オプション肘(左右セット)

ASO-M1575B/W P.045 ミーティングテーブル

ASO-CF6060B/W P.048 カフェテーブル

ASO-PB1530H P.051 NEW プランターボックス(ハイタイプ)


ASO-M1890B/W P.045 ミーティングテーブル

ASO-CF1040B/W P.048 カフェテーブル

ASO-PB1530L P.051 NEW プランターボックス(ロータイプ)

ASO-OC1 P.055 チェア ALES- □ -B P.056 チェアパッドなし黒塗装脚
スクリーン

ASO-SP3B/W P.058 抗ウィルススクリーン3連

ASO-SP1B/W P.058 抗ウイルススクリーン増設
ボックスソファ

ASO-BLS P.061 NEW 収納ボックスソファ
センター テーブル

ラウンジベンチ
ASO-L02B/W P.063

ASO-OT1260 P.061 抗ウイルスセンターテーブル

ASO-L02TB/W P.063 ラウンジベンチ(天板付)
ラウンジソファ

ASO-LS600N P.062 ラウンジソファ

ASO-L03B/W P.063 ラウンジベンチ
パーソナル ロッカー





システムベンチ

ASO-LS600S P.062 ラウンジソファ

ラウンジ サイドテーブル

ASO-SB900S P.064 NEW システムベンチ ASO-SB1200R P.064 NEW システムベンチ



ASO-LT8050 P.062 ラウンジサイドテーブル
ラウンジベンチ

ASO-S9060B/W P.065 シェルフ



ASO-L01B/W P.063 ラウンジベンチ

ASO-S9045B/W P.065 シェルフ

PRO-4W/B P.066
木製パーソナルロッカー PMR-3B






















005 PHOTO INDEX
シェルフ
ミニリーフG/W
I。
抗菌サークルボックス G-KB135 P.070 カシワバゴム1.35 G-AP15 P.070 アレカパーム1.5 G-STL16 P.070 ストレチア1.6 G-YK16 P.070 ユッカ1.6 G-OVT16 P.070 オリーブツリー1.6 G-TN18 P.070 トリネコ1.8 G-MS18 P.070 モンステラ1.8 G-MSG P.071 NEW ミックスグリーンS G-2TH P.071 ツートンホヤ G-PLP P.071 NEW ポールライムポトス G-TH P.071 ティグラスハンガー (ポリ製) G-FR P.071 壁掛けフィロ G-KSP P.071 壁掛けシュガーバイン G-PK90 P.071 パキラ90 G-GL P.071 ゴールデンリーフ G-B P.071 ベンジャミン G-GH P.071 NEW ウォーターグラスハンガー (ポリ製) G-WBDX P.072 ウッドボックスDX G-WBL P.072 ウッドボックスL G-TP2 P.073 ガーランドパーティション2連 ASO-SP3BLG+ASO-SP3BLG P.073 パーティション2連 G-TP1 P.073 ガーランドパーティション1連 ASO-SP3BLG P.073 パーティション1連 G-AGL P.073 アイビーガーランドラージ G-AG P.073 斑入りアイビーガーランド
P.067 NEW 木製パーソナルロッカー グリーン PHN-1200(MAK) P.068 プランターハンガー G-SMG P.068 ミックスグリーンS G-IB P.068 アイビー G-HIB P.068 斑入りアイビー G-MLL P.068 ミニリーフL G-MLGW P.068
CoMb
P.069

















KY-S300 P.095 キャスターチェア(背なし)


















OP-HP P.095 プラパーツ





OP-CS P.095 ゴムキャスター
マネジメント チェア

MG-140H P.096 マネジメントチェア
ネスティング チェア

KRM-430G P.099 ネスティングチェア
ミーティング
チェア


EL-4B-ZR- □□ P.104 エレッタミーティングチェア/背カバーなし


MG-140L P.096 マネジメントチェア

KRM-430 P.099 ネスティングチェア

EL-4W-ZR- □□ P.104 エレッタミーティングチェア/背カバーなし



オフィス チェア PLC-120H P.097 オフィスチェア PLC-120L P.097 オフィスチェア

EL-6B-ZR- □□ P.101 エレッタネスティングチェア/背カバー無

EL-4B-HS- □□ P.104 エレッタミーティングチェア/(ハンドルタイプ)


EL-6W-ZR- □□ P.101 エレッタネスティングチェア/背カバー無

EL-4W-HS- □□ P.104 エレッタミーティングチェア/(ハンドルタイプ)

EL-6B-HS- □□ P.101 エレッタネスティングチェア/(ハンドルタイプ)

EL-4B- □□ - □□

ロッキング チェア

EL-6W-HS- □□ P.101 エレッタネスティングチェア/(ハンドルタイプ)

□□ - □□ P.105 エレッタミーティングチェア/背カバー付


EL-8 P.098 NEW エレッタ ロッキングチェア

EL-6B- □□ - □□ P.102 エレッタネスティングチェア/背カバー付



EL-6W- □□ - □□ P.102 エレッタネスティングチェア/背カバー付


チェア


□







チェアパッドなしメッキ脚 ALES- □ -B P.112 チェアパッドなし黒塗装脚 ALES-P- □□ - □□□ P.113 NEW チェアパッド付メッキ脚 ALES-P- □□ - □□□ -B P.113 NEW チェアパッド付黒塗装脚 ALES-P- □□ - □□ P.113 チェアパッド付メッキ脚 ALES-P- □□ - □□ -B P.113 チェアパッド付黒塗装脚 ALES-P- □□ - □□□ P.113 チェアパッド付メッキ脚 ALES-P- □□








オフィスチェア
チェア オフィスチェア CKH22 P.075 NEW オフィスチェア メッシュ張り CKH22-AR P.075 NEW オプション肘(左右セット) CKH22-HR P.075 NEW オプションヘッドレスト CKH11 P.077 オフィスチェア メッシュ張り CKH11-AR P.077 オプション肘 (左右セット) CK01 P.079
メッシュ張り
SL-AL
(左右セット) KOL-F1 P.083 NEW オフィスチェア YSC 01 P.085 NEW スウィングチェア YSC01-AR P.085 NEW オプション肘 (左右セット) SKC-01 P.086 オフィスチェア SL-AR P.086 T型肘 SL-HG P.086 ハンガー ALPHA-G P.087 オフィスチェア 92AR(GR) P.087 オプション肘 (左右セット) K-921 P.089 オフィスチェア K-921PU P.089 NEW オフィスチェア K-922 P.090 オフィスチェア K-928 P.091 オフィスチェア ASO-OC1 P.092 チェア K-932 P.093 スタディチェア K-926 P.093 オフィスチェア スツール HP-330MS P.094 ワークスツール HP-330LG P.094 ワークスツール HP-330BK P.094 ワークスツール KYB-B300 P.095 NEW キャスターチェア(背付) KYB-S300 P.095
KY-B300
キャスターチェア(背付)
CK01-AR P.079 オプション肘 (左右セット) CK01-HR P.079 オプションヘッドレスト CK02 P.080 オフィスチェア メッシュ張り CK02-AR P.080・81 オプション肘 (左右セット)
P.080 ループ型肘 CK03 P.081 NEW オフィスチェア メッシュ張り LM1 P.082 オフィスチェア メッシュ張り 92AR P.082 オプション肘
NEW キャスターチェア(背なし)
P.095
OP-CPU
OP-NY P.095 NEW ナイロンキャスター
P.095 ウレタンキャスター
P.105 エレッタミーティングチェア/背カバー付
EL-4W-
SFIDA-C1 P.106 スフィーダキャスターチェア
SFIDA-B P.107 スフィーダミーティングチェア
MAC-25 P.107 マッキンリー台車 (25台用) SFIDA P.108 スフィーダミーティングチェア MK-480 P.109 マッキンリースタッキングチェア MEO-305 P.109 メモ台
木製チェア
ASO-WC2T P.110 木製チェア ASO-WC2F-NA P.110 木製チェア
ASO-WC1 P.111 木製チェア
ASO-WC1(別張り) P.111 木製チェア
ALES-
P.112
- □□□ -B P.113 チェアパッド付黒塗装脚
ALES-H- □□ -B P.114 チェアパッドなし黒塗装脚 ALES-HP- □□ - □□□ P.115 NEW チェアパッド付メッキ脚 ALES-HP- □□ - □□□ -B P.115 NEW チェアパッド付黒塗装脚 ALES-HP- □□ - □□ P.115 チェア (パッド付) ALES-HP- □□ - □□ -B P.115 チェアパッド付黒塗装脚 ALES-HP- □□ - □□□ P.115 チェアパッド付メッキ脚 006 PHOTO INDEX
ALES-P- □□ - □□□ P.113 チェアパッド付メッキ脚 ALES-P- □□ - □□□ -B P.113 チェアパッド付黒塗装脚 ALES-H- □□ P.114 チェアパッドなしメッキ脚









ALES-HP- □□ - □□□ -B
チェアパッド付黒塗装脚
P.115

チェアパッド付メッキ脚
ALES-TP- □□ - □□□ P.117
カウンター チェア

ダイニングチェア (肘なし)
DC-430P P.130
スツール


チェアパッド付メッキ脚
ALES-HP- □□ - □□□ P.115
ALES-HP- □□ - □□□ -B P.115 チェアパッド付黒塗装脚
ALES-T- □ P.116 チェア

ALES-TP- □□ - □□□ -B P.117 チェアパッド付黒塗装脚



ASO-CTB
チェア
ALES-T- □ -B P.116
ALES-TP- □□ - □□□ P.117 NEW チェアパッド付メッキ脚
ALES-TP- □□ - □□□ -B P.117 NEW チェアパッド付黒塗装脚
ALES-TP- □□ - □□ P.117 チェアパッド付メッキ脚
ALES-TP- □□ - □□ -B P.117 チェアパッド付黒塗装脚


ALES-CT






FC-570P P.130 折畳みチェア











ミーティング チェア



P.128 木製チェア

SC-20






DC-530P P.129 ダイニングチェア (肘付)
DC-730P P.130 ダイニングチェア (肘付)






SFS-430F P.131 NEW
スタッキングスツール TMO-S P.132 NEW 楕円型チェア(キャスターなし) TMO-SC P.132 NEW 楕円型チェア(キャスター付) TMO-N P.132 NEW 楕円型チェア(キャスターなし) TMO-NC P.132 NEW 楕円型チェア(キャスター付) TSN-ST P.132 NEW スツール













P.118 カウンターチェア ALES-CTB P.118 カウンターチェア
ハイチェア
P.119 カウンターチェア ASO-HC320C P.119
ASO-HC320W P.119 ハイチェア
P.120 ミーティングチェア チェア
P.121 NEW 樹脂チェア リフレッシュ チェア JCH-470B P.122 樹脂チェア JCH-470W P.122 樹脂チェア TCH-B P.123 チェア TCH-W P.123 チェア TCH-WC P.123 チェア
TCH-BC P.123 チェア (キャスター付) 折りたたみ チェア AFC-2A P.124 アルミ折畳みイス AFC-2APU P.124 アルミ折畳みイス (クッションパット付) FP-930 P.125 折畳みイス SFC-2M P.125 折畳みイス SFC-2T P.125 折畳みイス CRT-36S P.125 チェア台車 KCD-L27 P.125 チェア台車 KCD-T30
EA-CH
(キャスター付)
P.125 チェア台車 木製チェア
MC-620NA P.126 木製チェア MC-620BR P.126 木製チェア
木製チェア
MC-840NA P.127 木製チェア MC-840BR P.127
MC-510NA P.128 木製チェア MC-510BR
HM-320 P.133 木座スツール
ST-32TN P.133 スツール
ドーナツイス
P.133
ドーナツイス
丸イス P.133 丸イス
デスク・収納 昇降デスク
LDC-L127B/W P.135 昇降デスク
LDC-TP1270 P.135・139 トップパネル LDCデスク
LDC-K107-R3 P.136 片袖机 LDC-K127-R2 P.136 片袖机 LDC-H127 P.137 平机
P.137 両袖机 WJ-IN2 P.137 インワゴン WJ-IN3 P.137 インワゴン LDC-WD2 P.137 脇机 LDC-WD3 P.137 脇机 LDC-AJ P.137 オプションアジャスター KFP-1000 P.138 フェルトトップパネル 固定型 KFP-1200 P.138 フェルトトップパネル 固定型 トップパネル 007 PHOTO INDEX
LDC-R147-LR23







スチール書庫

フェルトトップパネル 固定型
KFP-1400 P.138

LDC-H90S P.140 スチール書庫(スチール扉)
KAP-1000 P.138 クリアトップパネル

LDC-H90R P.140 スチール書庫(両開き扉)




NDW-45BT

KAP-1200 P.138 クリアトップパネル

LDC-B90 P.140 スチール書庫用ベース



パーティション

MPB-1806A
P.151 NEW パネルA (全面布)

MPB-1212A
パネルA (全面布)
P.151 NEW

MPB-1509UAR
パネルU (上部透明)
P.151 NEW





KAP-1400 P.138 クリアトップパネル

LDC-9040-TOP P.141 スチール書庫用天板
ACS-900 P.139 アクリルスクリーン
KVP-60 P.139 飛沫防止パネル
KVP-90 P.139 飛沫防止パネル

LDC-1840-TOP P.141 スチール書庫用天板 パーソナル ロッカー PRO-4W P.142 木製パーソナルロッカー





吸音集中ブース

MPB-1809A
P.151 NEW パネルA (全面布)

MPB-1809FAR
パネルF (全面透明)
P.151 NEW



QSB-1810T P.149 吸音集中ブース(扉付)

MPB-1812A
P.151 NEW パネルA (全面布)

MPB-1209U
パネルU (上部半透明)
P.151 NEW





QSB-1510
P.149 吸音集中ブース

MPB-1506A
P.151 NEW パネルA (全面布)

MPB-1509U
P.151 NEW






PRO-4B P.142 NEW 木製パーソナルロッカー


LDC-H90N P.140 スチール書庫(オープン)

PMR-3B P.143 NEW 木製パーソナルロッカー


一人用デスク・ テーブル

MPB-1509A
P.151 NEW パネルA (全面布)




ASO-WD6050B P.149 ワークデスク

MPB-1512A P.151 NEW パネルA (全面布)




ASO-WT6045B P.149 ワークテーブル

MPB-1207A
P.151 NEW パネルA (全面布)

AHM-6545VH P.149 抗ウイルスフォールディングテーブル

MPB-1209A
P.151 NEW パネルA (全面布)


 MPBシリーズ
パネルU (上部半透明)
MPB-1812U P.151 NEW パネルU (上部半透明)
MPB-1812F P.151 NEW パネルF (全面半透明)
MPBシリーズ 防炎タイプ
MPB-1812AB P.152 パネルA (全面布)
MPB-1512AB P.152 パネルA (全面布)
MPB-1212AB P.152 パネルA (全面布) パネルU (上部透明)
MPB-1209UB P.152 パネルU (上部半透明) MPB-1509UB パネルU (上部半透明) MPB-1812UB P.152 NEW パネルU (上部半透明)
MPB-1212F P.152 NEW パネルF (全面半透明)
MPBシリーズ
パネルU (上部半透明)
MPB-1812U P.151 NEW パネルU (上部半透明)
MPB-1812F P.151 NEW パネルF (全面半透明)
MPBシリーズ 防炎タイプ
MPB-1812AB P.152 パネルA (全面布)
MPB-1512AB P.152 パネルA (全面布)
MPB-1212AB P.152 パネルA (全面布) パネルU (上部透明)
MPB-1209UB P.152 パネルU (上部半透明) MPB-1509UB パネルU (上部半透明) MPB-1812UB P.152 NEW パネルU (上部半透明)
MPB-1212F P.152 NEW パネルF (全面半透明)
MPB-FK P.153 NEW 安定脚 MPB-F P.153 NEW 安定脚 MP-K P.153 キャスター脚 MP-AJ P.153 アジャスター脚 MPB-JK18 P.153 NEW 可動連結セット (2方向) MP-J P.153 MPシリーズオプション
P.153 MPシリーズオプション PCP-102 P.153 パンフレットケース シェルフ ASO-S9060B/W P.144 シェルフ ASO-S9045B/W P.144 シェルフ 食器棚 SDP-1800 P.145 食器棚 ファイルワゴン NFW-460 P.146 ファイルワゴン
P.146 ファイルワゴン
P.146 ファイルワゴン
MPB-2J(2 方向) P.153 NEW 簡易固定連結樹脂セット MPB-3J(3方向) P.153 NEW 簡易固定連結樹脂セット MPB-4J(4方向) P.153 NEW 簡易固定連結樹脂セット
MP-H
NFW-660
NFW-860
ファイルワゴン
ファイルワゴン
ファイルワゴン
ファイルワゴン
ファイルワゴン OKW-35
NFW-463 P.146
NFW-663 P.146 ファイルワゴン NFW-863 P.146
KFW-20 P.146
KFW-30 P.146
KFW-40 P.146
P.146 ファイルワゴン OKW-36 P.146 ファイルワゴン NDW-19L P.147 アンダーデスクワゴン
P.147 アンダーデスクワゴン KAW-12 P.147 フロアケース KAW-13 P.147 フロアケース
YA4PT-118N P.147 フロアケース
YA4PT-209N P.147 フロアケース KBS-70 P.147 ファイルスタンド FB-3 P.147 フリーボックス
008 PHOTO INDEX
MPシリーズ

MP-1207A
パネルA (全面布)
P.156

MP-1212AB
パネルA (全面布)
P.157









パネルA (全面布)
MP-1812A P.156

MP-1509UAR P.156 パネルU (上部透明)

パネルU (上部透明)
MP-1509UARB P.157

パネルA (全面布)
MP-1809A P.156

MP-1809FAR P.156 パネルF (全面透明)

MP-1812UB P.157 パネルU (上部半透明)
MP-FK P.158 安定脚 MP-F P.158 安定脚 MP-JK18 P.158 可動連結セット (2方向)
AP-Vシリーズ

AP-1812V P.163 抗ウイルスパーティション
PSBシリーズ



PSB-1809A P.165 NEW アルミパーティション





AP-1810V P.163 抗ウイルスパーティション

PSB-1810A P.165 NEW アルミパーティション






パネルA (全面布)
MP-1806A P.156

パネルU (上部半透明)
MP-1812U P.156

パネルU (上部半透明)
MP-1509UB P.157
VMPシリーズ


PSB-1812A P.165 NEW アルミパーティション



パネルA (全面布)
MP-1512A P.156

MP-1509A P.156 パネルA (全面布)

パネルU (上部半透明)
MP-1509U P.156

MP-1209U P.156 パネルU (上部半透明)

パネルU (上部半透明) MP-1212F P.157 パネルF (全面半透明)
MP-1209UB P.157




MP-1506A P.156
パネルA (全面布)

MP-1812F P.156 パネルF (全面半透明)

MP-2J(2 方向) P.158 簡易固定連結樹脂セット

VMP-1812A P.160 抗ウイルスパーティション VMP-1809A P.160 抗ウイルスパーティション VMP-1806A P.160 抗ウイルスパーティション

AP-1809V P.163 抗ウイルスパーティション AP-1512V P.163 抗ウイルスパーティション AP-1510V P.163 抗ウイルスパーティション AP-1209V P.163 抗ウイルスパーティション

PSB-1509A P.165 NEW アルミパーティション


PSB-1510A P.165 NEW アルミパーティション

PSB-1512A P.165 NEW アルミパーティション




KPZシリーズ









MP-1212A P.156
パネルA (全面布)

MP-1209A P.156 パネルA (全面布)

MP-1812AB P.157
パネルA (全面布)

MP-3J(3方向) P.158 簡易固定連結樹脂セット
MP-1512AB P.157 パネルA (全面布)

MP-4J(4方向) P.158 簡易固定連結樹脂セット

AP-1207V P.163 抗ウイルスパーティション

PSB-1209A P.165 NEW アルミパーティション





PSB-1212A P.165 NEW アルミパーティション




SMPシリーズ
 PSB-1509F P.165 NEW 全面透明パネル
PSB-1512F P.165 NEW 全面透明パネル
PSB-JK18 PSB-JK15 P.166 NEW 連結支柱
TPA-RF P.166 安定脚 TPA-FK P.166 キャスター脚 PSAシリーズ
PSA-1812A P.167 アルミパーティション
PSA-1810A P.167 アルミパーティション PSA-1809A P.167 アルミパーティション
PSA-1512A P.167
アルミパーティション
PSA-1510A P.167 アルミパーティション
PSA-1509A P.167 アルミパーティション
PSA-1212A P.167 アルミパーティション
PSA-1209A P.167 アルミパーティション
PSA-1512F P.167 全面透明パネル
PSA-1509F P.167 全面透明パネル
PSA-2J P.168 連結金具 (2方向用)
PSA-MJ P.168 連結金具 (3方向・4方向用)
PSA-JK18
PSA-JK15 P.168 連結支柱
PSA-RF P.168 安定脚 (両脚タイプ)
PSA-F P.168 安定脚(片脚タイプ)
PSA-FK P.168 安定脚 (キャスター脚タイプ)
KPZ-DR2109V/P/F P.171 システムパーティション
KPZ-2112V P.171 システムパーティション KPZ-1812P P.171 システムパーティション KPZ-1512V P.171 システムパーティション
KPZ-JK21SJ P.172 直線連結支柱
KPZ-JK21LJ P.172 L型連結支柱
KPZ-JK213J P.172 3方向連結支柱
PSB-1509F P.165 NEW 全面透明パネル
PSB-1512F P.165 NEW 全面透明パネル
PSB-JK18 PSB-JK15 P.166 NEW 連結支柱
TPA-RF P.166 安定脚 TPA-FK P.166 キャスター脚 PSAシリーズ
PSA-1812A P.167 アルミパーティション
PSA-1810A P.167 アルミパーティション PSA-1809A P.167 アルミパーティション
PSA-1512A P.167
アルミパーティション
PSA-1510A P.167 アルミパーティション
PSA-1509A P.167 アルミパーティション
PSA-1212A P.167 アルミパーティション
PSA-1209A P.167 アルミパーティション
PSA-1512F P.167 全面透明パネル
PSA-1509F P.167 全面透明パネル
PSA-2J P.168 連結金具 (2方向用)
PSA-MJ P.168 連結金具 (3方向・4方向用)
PSA-JK18
PSA-JK15 P.168 連結支柱
PSA-RF P.168 安定脚 (両脚タイプ)
PSA-F P.168 安定脚(片脚タイプ)
PSA-FK P.168 安定脚 (キャスター脚タイプ)
KPZ-DR2109V/P/F P.171 システムパーティション
KPZ-2112V P.171 システムパーティション KPZ-1812P P.171 システムパーティション KPZ-1512V P.171 システムパーティション
KPZ-JK21SJ P.172 直線連結支柱
KPZ-JK21LJ P.172 L型連結支柱
KPZ-JK213J P.172 3方向連結支柱
4方向連結支柱 KPZ-HS P.172 直線ストッパー
L型ストッパー
KPZ-JK214J P.172
KPZ-HL P.172
KPZ-H3 P.172
3方向ストッパー
KPZ-H4 P.172
4方向ストッパー
KPZ-HE P.172 エンドストッパー
KPZ-EC21LJ P.173 L型エンドカバー
KPZ-EC213J P.173 3方向エンドカバー
両面用ベース KPZ-BR P.173 丸ベース
KPZ-EC21SJ P.173 エンドカバー KPZ-B100 P.173
KPZ-BE P.173 エンド用ベース
KPZ-B75 P.173
75角ベース
009 PHOTO INDEX
SMP-1809MP P.177 マグネットパーティション









マグネットパーティション
SMP-1806MP P.177

マグネットパーティション
SMP-1509MP P.177

SMP-1809PC(CR) P.177




KPVシリーズ


SMP連結金具セット SMP-4J P.178 SMP連結金具セット SMP-FK P.178 SMP安定脚 (キャスター脚) SMP-F P.178 SMP安定脚 (アジャスター脚) SMP-3CL(BL) P.178 SMP三つ折パーティション SMP-3PC(CR) P.178 SMP三つ折パーティション
マグネットパーティション SMP-1806PC(CR) P.177 マグネットパーティション SMP-1509PC(CR) P.177 マグネットパーティション SMP-1809AR P.177 マグネットパーティション SMP-1509AR P.177 マグネットパーティション SMP-SJ P.178 SMP連結金具セット SMP-LJ P.178 SMP連結金具セット SMP-3J P.178
KPV-21-3P P.181 パーティション3連




VNRシリーズ


パーティション3連
KPV-15-3F P.181
楢シリーズ
木目単体パネル

KPV-21-4P P.181 パーティション4連

楢 -66C P.184 三ッ折衝立

SKN-1812SK P.187 自立パネル (両面木目)
KPV-18-4V P.181 パーティション4連

楢 -88CB P.184 三ッ折衝立

SKN-1809SK P.187 自立パネル (両面木目)

KPV-15-4F P.181 パーティション4連

楢 -66 P.185 三ッ折衝立

SKN-1812SK+SPJ-0001 P.187 自立パネル (両面木目)キャスター仕様


楢 -88 P.185 三ッ折衝立



TPA-W1509B P.190 単体アルミパーティション
アルミ

TPA-R1809B P.191 単体アルミパーティション


スクリーン衝立





VNR-88K P.183
抗ウイルス三ツ折衝立 VNR-66K P.183 抗ウイルス三ツ折衝立
ASO-SP

SKN-1809SK+SPJ-0001 P.187 自立パネル (両面木目)キャスター仕様 SPJ-0001 P.187 キャスタ− (1set 4個入)



ASO-SP3B P.186 抗ウィルススクリーン3連 ASO-SP1W P.186 抗ウイルススクリーン増設
展示パネル

TEM-MG P.188 マグネット TEP-JK P.188 支柱 TEP-RB P.188 丸ベース TEP-SB P.188 安定脚 TEY-1809 P.189 両面有孔ボード展示パネル TEY-1209 P.189 両面有孔ボード展示パネル TEY-LHK3 P.189 有孔ボード展示パネル用L型フック (3個入り)





TEM-1809 P.188 両面ピン・マグ展示パネル
TPAシリーズ

AA・AAC シリーズ


APF-1812F P.193
アルミパーティション (安定脚タイプ)
アルミパーティション














AA-188+AAC-128 P.194 アコーディオンスクリーン
AA-188 P.194 アコーディオンスクリーン




KPV-18-3V P.181
パーティション3連

TEM-1209 P.188 両面ピン・マグ展示パネル

TPA-W1809B P.190 単体アルミパーティション


AAC-121 P.194 アコーディオンスクリーン
 TPA-R1509B P.191 単体アルミパーティション
TPA-A1809B P.191 単体アルミパーティション
TPA-A1509B P.191 単体アルミパーティション
TPA-V1809B P.192 単体アルミパーティション TPA-V1509B P.192 単体アルミパーティション
TPA-M1809B P.192 単体アルミパーティション
TPA-M1509B P.192 単体アルミパーティション
パーティション
APF-1809F P.193
(安定脚タイプ)
APF-1812FK P.193 アルミパーティション (キャスター脚タイプ) APF-1809FK P.193 アルミパーティション (キャスター脚タイプ)
AA-158 P.194 アコーディオンスクリーン
AXシリーズ
TPA-R1509B P.191 単体アルミパーティション
TPA-A1809B P.191 単体アルミパーティション
TPA-A1509B P.191 単体アルミパーティション
TPA-V1809B P.192 単体アルミパーティション TPA-V1509B P.192 単体アルミパーティション
TPA-M1809B P.192 単体アルミパーティション
TPA-M1509B P.192 単体アルミパーティション
パーティション
APF-1809F P.193
(安定脚タイプ)
APF-1812FK P.193 アルミパーティション (キャスター脚タイプ) APF-1809FK P.193 アルミパーティション (キャスター脚タイプ)
AA-158 P.194 アコーディオンスクリーン
AXシリーズ
AX-198 P.195 NEW アコーディオンスクリーン
AX-193 P.195 NEW アコーディオンスクリーン AX-196 P.195 NEW アコーディオンスクリーン AX-1920 P.195 NEW アコーディオンスクリーン
AS-150K P.197 NEW スクリーン衝立 (一本立) AS-46-2K P.197 NEW スクリーン衝立 折畳み
AS-46-3K P.197 NEW スクリーン衝立 折畳み
AS-46-4K P.197 NEW スクリーン衝立
AM-621-CLA P.198 NEW スクリーン衝立 AM-632-CLA P.198 NEW スクリーン衝立 AM-613-CLA P.198 NEW スクリーン衝立 AM-664-CLA P.198 NEW スクリーン衝立 AM-631-CL P.199 NEW スクリーン衝立 AM-622-CL P.199 NEW スクリーン衝立 AM-613-CL P.199 NEW スクリーン衝立 AM-664-CL P.199 NEW スクリーン衝立
AS-180 P.196 NEW スクリーン衝立 (一本立) AS-46-2 P.196 NEW スクリーン衝立 折畳み (二ツ折) AS-56-3 P.196 NEW スクリーン衝立 折畳み (三ツ折) AS-56-4 P.196 NEW スクリーン衝立 折畳み (四ツ折)
(二ツ折)
(三ツ折)
折畳み (四ツ折)
010 PHOTO INDEX
テーブル ワークテーブル

ワークテーブル
ASO-WH1811B P.202

FDC-1212W P.205 ワークテーブル
インワゴン

ASO-WH1811W P.203 ワークテーブル

FDC-2412B P.204 ワークテーブル

ASO-W1111B P.201 ワークテーブル


ASO-W1111W P.201 ワークテーブル


ASO-W1811B P.201 ワークテーブル

FDC-2412W P.204 ワークテーブル CDT P.204 オプションコードトレー HD-790 P.204 配線ダクト

ASO-W1811W P.201 ワークテーブル

FDC-3612B P.205 ワークテーブル

ワークテーブル
ASO-W2411B P.201

FDC-3612W P.205 ワークテーブル

ASO-W2411W P.201 ワークテーブル

FDC-1212B P.205 ワークテーブル



WJ-IN2(WH) P.205 インワゴン
ミーティング テーブル


ASO-DT1290B P.208 ミーティングテーブル
抗ウイルス テーブル
WJ-IN3(WH) P.205 インワゴン

ASO-M1575B P.209 ミーティングテーブル

WJ-IN3(BK) P.205 インワゴン

ASO-M1890B P.209 ミーティングテーブル

大型会議 テーブル

ASO-M1575W P.209 ミーティングテーブル


NOTK-2412 P.207 大型会議テーブル (角型)

ASO-M1890W P.209 ミーティングテーブル

NOTD-2412 P.207 大型会議テーブル (楕円型)

TA-2190B P.210 ミーティングテーブル

NOTF-3612 P.207 大型会議テーブル (舟型)

TA-1575B P.210 ミーティングテーブル

VTA-1575B P.210
抗ウイルスミーティングテーブル
跳ね上げ式 会議テーブル


BA-3KV P.211 抗ウイルステーブル

VKS-1890 P.212 抗ウイルス会議テーブル (角型)
VKS-D1890 P.212 抗ウイルス会議テーブル (楕円型)






AHK-1890S P.213
跳ね上げ式会議テーブル (シルバー塗装)

SHM-JM1845 P.214
跳ね上げ式会議 テーブル (幕板付き)
跳ね上げ式 会議テーブル
SHM-JM1545 P.214
跳ね上げ式会議 テーブル (幕板付き)

AHM-1860 P.216


跳ね上げ式会議テーブル (ダークグレー塗装)
AHK-1890 P.213
フォールディング テーブル



抗ウイルス跳ね上げ式会議 テーブル (ダークグレー塗装)
VAHK-1890 P.213

AHM-1845VH P.215
抗ウイルス フォールディングテーブル


VAHK-1890S P.213
SHM-JM1860
抗ウイルス跳ね上げ式会議 テーブル (シルバー塗装)

AHM-JM1845VH P.215
抗ウイルスフォールディング テーブル (幕板付)



SHM-1860 P.214
跳ね上げ式会議テーブル
SHM-1845 P.214 跳ね上げ式会議テーブル






SHM-1560 P.214
跳ね上げ式会議テーブル
跳ね上げ式会議 テーブル (幕板付き)

抗ウイルス跳ね上げ式
VTA-1890B P.210 抗ウイルスミーティングテーブル
P.214
跳ね上げ式会議テーブル AHM-1545 P.216 跳ね上げ式会議テーブル
AHM-7550 P.216 跳ね上げ式会議テーブル
AHM-JM1860 P.216 跳ね上げ式 会議テーブル(幕板付き)
VAHM-1845 P.217 抗ウイルス跳ね上げ式 会議テーブル
VAHM-JM1845 P.217
抗ウイルス跳ね上げ式 会議テーブル (幕板付)
VAHM-JM1860 P.217
会議テーブル (幕板付)
研修用デスク
AHM-6545 P.218
跳ね上げ式研修用デスク
AHM-JM6545 P.218 跳ね上げ式研修用 デスク (幕板付き)
VAHM-6545 P.218
抗ウイルス跳ね上げ式 研修用デスク
VAHM-JM6545 P.218
抗ウイルス跳ね上げ式
研修用デスク (幕板付)
AHM-6545VH P.219 抗ウイルス フォールディングテーブル
AHM-JM6545VH P.219 抗ウイルスフォールディング テーブル (幕板付)
抗ウイルス 昇降テーブル
VLTC-L1890 P.220
抗ウイルス昇降テーブル VLTC-L1575 P.220 抗ウイルス昇降テーブル
会議テーブル
抗ウイルス
VKT-TN6545BBSE P.221 抗ウイルス会議テーブル
(バネ脚)
VKT-TN9045BBSE P.221 抗ウイルス会議テーブル (バネ脚)
011 PHOTO INDEX
VKT-TN1245BBSE P.221 抗ウイルス会議テーブル (バネ脚)
折り畳み 会議テーブル

YKT-1560
折畳み会議テーブル (共張り)
P.223









抗ウイルス折畳み会議 テーブル (シルバー塗装)
VKT-1845S P.222

折畳み会議テーブル (共張り)
YKT-1545 P.223

折畳み会議テーブル
WLB-1845SE P.224

KTZ-L1545HSE
折畳み会議テーブル (座卓兼用)
P.226
座卓
ブロー成型 テーブル
宴会テーブル

TU-1845TSE P.224
折畳み会議テーブル

抗ウイルス折畳み会議 テーブル (シルバー塗装)
VKT-1860S P.222

折畳み会議テーブル (共張り)
YKT-1260 P.223

TU-1845 P.224
折畳み会議テーブル

YKZ-1845H P.227 折畳み座卓 (平板脚) YKZ-1845HSE P.227 折畳み座卓 (平板脚)




VKT-1890S P.222
抗ウイルス折畳み会議 テーブル (シルバー塗装)

VKT-1845B P.222 抗ウイルス折畳み会議 テーブル (ブラック塗装)

折畳み会議テーブル (共張り)
YKT-1245 P.223

WL-1845TSE P.225 折畳み会議テーブル (ワイドワランク脚)

YKZ-1545 P.227 折畳み座卓


BT-1860B P.230
ブロー成型テーブル

ET-900R P.232
宴会テーブル (円型)


ブロー成型テーブル
BT-1860S P.230

ET-1200R P.232
宴会テーブル (円型)



VKT-1860B P.222
抗ウイルス折畳み会議 テーブル (ブラック塗装)

YKT-1890SE P.223
折畳み会議テーブル (ソフトエッジ)

折畳み会議テーブル (ワイドワランク脚)
WL-1845SE P.225

YKZ-1545SE P.227 折畳み座卓


CBT-1845S P.231
ブロー成型テーブル (スライド脚)

ET-1500RH P.232
宴会テーブル (半円型)



抗ウイルス折畳み会議 テーブル (ブラック塗装)
VKT-1890B P.222

YKT-1845SE P.223
折畳み会議テーブル (ソフトエッジ)

WL-1845 P.225
折畳み会議テーブル (ワイドワランク脚)

RWZ-1845 P.227 折畳み座卓


CBT-1845S P.231
ブロー成型テーブル (スライド脚)

ET-1800RH P.232
宴会テーブル (半円型)


ブロー成型座卓(スライド脚)
CBT-Z1845S P.231

ET-1890 P.232


YKT-1560SE P.223
折畳み会議テーブル (ソフトエッジ)

KTZ-1845 P.225 折畳み会議テーブル (座卓兼用)
高さ調節脚 テーブル


CBT-Z1845S P.231 ブロー成型座卓(スライド脚)

宴会テーブル (長方形) ET-1875 P.232 宴会テーブル

YKT-1890 P.223
折畳み会議テーブル (共張り)

折畳み会議テーブル (ソフトエッジ)
YKT-1260SE P.223

折畳み会議テーブル (座卓兼用)
KTZ-1845SE P.225

KG-1845 P.228 昇降機能付折畳み会議テーブル

HTC-6045W P.229 天板付きワゴン


YKT-1860 P.223
折畳み会議テーブル (共張り)

WLB-1845TSE P.224
折畳み会議テーブル

KTZ-L1845HSE P.226
折畳み会議テーブル (座卓兼用)

RN-8 P.228 テーブル台車 (8台用)

HTC-4545W P.229 天板付きワゴン
 (長方形) ETZ-1200 P.233 フライト式宴会テーブル
ETZ-K1860 P.233 フライト式宴会テーブル
TT-900 P.233 ターンテーブル
カフェテーブル
ASO-CF750B P.234 カフェテーブル
ASO-CF750W P.234
カフェテーブル
(長方形) ETZ-1200 P.233 フライト式宴会テーブル
ETZ-K1860 P.233 フライト式宴会テーブル
TT-900 P.233 ターンテーブル
カフェテーブル
ASO-CF750B P.234 カフェテーブル
ASO-CF750W P.234
カフェテーブル
カフェテーブル ラウンジ テーブル
P.235 ラウンジテーブル CFL-T80B P.235 ラウンジテーブル VCFL-T80S P.235 抗ウイルスラウンジテーブル VCFL-T80B P.235 抗ウイルスラウンジテーブル CFH-T60B P.235 ハイテーブル VCFH-T60S P.235 抗ウイルスハイテーブル VCFH-T60B P.235 抗ウイルスハイテーブル プランター テーブル ASO-PT1790 P.236 プランターテーブル ASO-PT1271KH P.236 プランター片面ハイテーブル ASO-PT1211RH P.236 プランター両面ハイテーブル 作業台
ASO-CF7575B P.234 カフェテーブル
ASO-CF7575W P.234
CFL-T80
SUP-1875WWK P.229 作業台 SUP-1575WWK P.229 作業台 SUP-960-WWK P.229 作業台 SUPH-1875WWK P.229 作業台 SUPH-1560WWK P.229 作業台 HTC-7545W P.229 天板付きワゴン
012 PHOTO INDEX
カウンター






テーブル
ラウンジ テーブル
ワークテーブル


カウンターテーブル
ASO-CT1845B P.237

ASO-T1575B
P.238 NEW テーブル

カフェテーブル
ASO-CF1260B P.240

カウンターテーブル
ASO-CT1845W P.237

抗ウイルス食堂用 テーブル (椅子掛け付)
SIK-1875VA P.239

ASO-CF1260W P.240 カフェテーブル
ASO-WT6045B P.241 ワークテーブル サイドテーブル










カウンターテーブル (幕板付)
ASO-CT1845MW P.237

ASO-HCT1845B P.237 カウンターテーブル
ASO-HCT1845W P.237 カウンターテーブル
ASO-HCT1845MB P.237
カウンターテーブル (幕板付)
抗ウイルス食堂用 テーブル (椅子掛け付)
SIK-1875VM P.239

ASO-CF6060B P.240 カフェテーブル

ASO-ST400B P.241 サイドテーブル



ASO-CF6060W P.240 カフェテーブル ASO-CF1040B P.240 カフェテーブル

ASO-ST4540B P.241 サイドテーブル

ワークデスク

ASO-CF1040W P.240 カフェテーブル

ASO-WD6050B P.241




ラウンジチェア

キャスターチェア










山中サイドテーブル P.249 サイドテーブル



 応接ソファ
NZH-1 P.242 応接ソファ
NZH-2 P.242 応接ソファ NZH-3 P.242 応接ソファ NZ-A1 P.243 応接ソファ NZ-A2 P.243 応接ソファ NZ-A3 P.243 応接ソファ
NZ-1 P.244 応接ソファ
NZ-2 P.244 応接ソファ NZ-3 P.244 応接ソファ
LKC-580 P.245 NEW ラウンジチェア
応接イス
KOT-580 P.246 応接イス KOT-1080 P.246 応接イス
ZCL-590 P.247 キャスターチェア ZC-590 P.247 キャスターチェア
応接テーブル
ASO-OT1260 P.248 NEW 抗ウイルスセンターテーブル KVT-1260 P.248 センターテーブル
OT-1260 P.249 センターテーブル
OT-4560 P.249 サイドテーブル
山中センターテーブル P.249 センターテーブル
TA-1260B P.249 センターテーブル
テーブル
応接ソファ
NZH-1 P.242 応接ソファ
NZH-2 P.242 応接ソファ NZH-3 P.242 応接ソファ NZ-A1 P.243 応接ソファ NZ-A2 P.243 応接ソファ NZ-A3 P.243 応接ソファ
NZ-1 P.244 応接ソファ
NZ-2 P.244 応接ソファ NZ-3 P.244 応接ソファ
LKC-580 P.245 NEW ラウンジチェア
応接イス
KOT-580 P.246 応接イス KOT-1080 P.246 応接イス
ZCL-590 P.247 キャスターチェア ZC-590 P.247 キャスターチェア
応接テーブル
ASO-OT1260 P.248 NEW 抗ウイルスセンターテーブル KVT-1260 P.248 センターテーブル
OT-1260 P.249 センターテーブル
OT-4560 P.249 サイドテーブル
山中センターテーブル P.249 センターテーブル
TA-1260B P.249 センターテーブル
テーブル
ワークデスク
ロビー 013 PHOTO INDEX ラウンジベンチ ASO-L01B P.250 ラウンジベンチ ASO-L01W P.250 ラウンジベンチ ASO-L02TB P.250 ラウンジベンチ(天板付)
P.250 ラウンジベンチ(天板付)
P.251 ラウンジベンチ
レセプション
ASO-L02TW
ASO-L02B
P.251 ラウンジベンチ
ASO-L02W
P.251 ラウンジベンチ
P.251 ラウンジベンチ ASO-LT8050 P.251 ラウンジサイドテーブル システムベンチ
P.252 NEW システムベンチ ASO-SB900S P.252 NEW システムベンチ ボックスソファ ASO-BLS P.253 NEW 収納ボックスソファ
ASO-L03B
ASO-L03W
ASO-SB1200R
ラウンジ テーブル

カフェテーブル
ASO-CF7575W P.255

ASO-CF6060B P.254 カフェテーブル

ASO-CF750B P.255 カフェテーブル

ASO-CF6060W P.254 カフェテーブル

ASO-CF750W P.255 カフェテーブル
システムソファ


RO-S600 P.256 背付きストレート


RO-S1200 P.256 背付きストレート

ASO-CF1040B P.254 カフェテーブル

ASO-WT6045B P.255 ワークテーブル

RO-S1800 P.256 背付きストレート

ASO-CF1040W P.254 カフェテーブル

ASO-ST400B P.255 サイドテーブル

RO-SL90 P.257 背付きコーナー
























ASO-CF1260B P.254 カフェテーブル

ASO-ST4540B P.255 サイドテーブル


ASO-CF1260W P.254 カフェテーブル
















ラウンジサイドテーブル
ASO-LT8050 P.254
ASO-CF7575B P.255 カフェテーブル












014 PHOTO INDEX エクステリア 樹脂ベンチ JA-1 P.266 樹脂ベンチ JA-1A P.266 樹脂ベンチ JA-1N P.267 樹脂ベンチ JA-1AN P.267 樹脂ベンチ JA-2 P.267 樹脂ベンチ JA-2N P.267 樹脂ベンチ
ZZW-1800 P.265 ロビーチェア ZZW-1500 P.265 ロビーチェア ZZ-1800 P.265 ロビーチェア背無し ZZ-1500 P.265 ロビーチェア背無し LZS-1800 P.265 ロビーチェア LZS-1500 P.265 ロビーチェア LZ-1800 P.265 ロビーチェア LZ-1500 P.265 ロビーチェア
ロビーチェア
RO-SC90 P.257 背付きコーナー RO-SR90 P.257 背付きコーナー RO-SOR90 P.257 背付き外アールコーナー RO-SIR90 P.257 背付き内アールコーナー RO-N600 P.257 スツール RO-NR600 P.257 コーナースツール ロビーチェア RD-52 P.258 ロビーチェア RD-52C P.258 ロビーチェア RD-53 P.259 ロビーチェア RD-54 P.259 ロビーチェア RD-42 P.259 ロビーチェア RD-42C P.259 ロビーチェア RD-43 P.259 ロビーチェア RD-44 P.259 ロビーチェア KUMIKI スツール KUMI-450H P.260 箱 KUMI-900H P.260 箱 KUMI-450T P.260 天板 KUMI-900T P.260 天板 KUMI-450F P.261 クッション (布張) KUMI-900F P.261 クッション (布張) KUMI-450F P.261 クッション (PVC張) KUMI-900F P.261 クッション (PVC張) キッズガーデン
KID-1150 P.262 スツール・シューズBOX KID-900 P.262 スツール・シューズBOX KID-B925 P.262 スツール・シューズBOX KID-K10 P.262 クッション KID-K20 P.262 クッション KID-K30 P.262 クッション
KID-M90 P.262 マット (入口・コーナー)
KID-C1150 P.262 マット (入口・コーナー)
KID-I250 P.262 マット (入口・コーナー)
ラウンジソファ
絵本ラック ENR-S P.263 絵本ラックスタンド ENR-O P.263 絵本ラックオープン ENR-K P.263 絵本ラックkumiki KUMI-350H P.263 箱 KUMI-350F P.263 クッションPVC張り
ASO-LS600S P.264 ラウンジソファ
ASO-LS600N P.264 ラウンジソファ
ウッドベンチ

CW-1 P.268 ウッドベンチ
カラーベンチ








FB-3S
折畳みカラーベンチ
P.270
アルミベンチ

ALB-5
P.272 アルミベンチ (背付)
木製ベンチ

CW-1A P.268 ウッドベンチ

FB-4S P.270 折畳みカラーベンチ

ALB-6 P.272 アルミベンチ (背なし)

CW-2 P.268 ウッドベンチ

FB-1B
折畳みカラーベンチ (背付)
P.270

AFB-1S P.272 バネ脚折畳みアルミベンチ (背なし)
CW-11 P.269 ウッドベンチ CW-11A P.269 ウッドベンチ CW-12 P.269 ウッドベンチ



FB-2B P.270 折畳みカラーベンチ (背付) B-4(1800) P.271 カラーベンチ (背なし) B-4(1500) P.271 カラーベンチ (背なし)

MB-1830 P.272 木製ベンチ MB-1530 P.272 木製ベンチ パラソル FAP-210 P.273 パラソル GA-S33 P.273 パラソルスタンド









































ABT4 P.269
ウッドベンチ

SW-480 P.269 ウッドベンチ

B-3(1800) P.271
カラーベンチ (背付)
B-3(1500) P.271 カラーベンチ (背付)









アクセサリー 015 PHOTO INDEX
AL-P40C P.274 アルミチェア AL-P53AC P.274 アルミアームチェア AL-P60RT P.274 アルミテーブル AL-F90RT P.275 アルミフォールディングテーブル AL-53AC P.275 アルミアームチェア AL-W53AC P.275 アルミアームチェア 傘立て K-27T P.276 傘立て K-48T P.276 傘立て K-92T P.276 傘立て K-102T P.276 傘立て KVO48 P.276 傘立てオプションカバー KVO102 P.276 傘立てオプションカバー K-27S P.277 傘立て K-48S P.277 傘立て K-92S P.277 傘立て K-102S P.277 傘立て KS-27S P.277 傘立て KS-48S P.277 傘立て KS-92S P.277 傘立て KS-102S P.277 傘立て K-F48T P.278 折畳み式傘立て K-F92T P.278 折畳み式傘立て K-F57A P.278 折畳み式傘立て K-F81A
BUS-25 P.278 アンブレラスタンド BUS-26 P.278 アンブレラスタンド KAS-1 P.278 傘袋スタンド KAS-2 P.278 かさっぱふくろト−ル KAS-B P.278 傘袋 AS-9 P.279 傘立て AS-18 P.279 傘立て
AS-P18 P.279 アルミパネル式傘立て AS-P27 P.279 アルミパネル式傘立て 消毒液スタンド FPS-90 P.279 ペダル式消毒液スタンド (シングルタイプ)
ペダル式消毒液スタンド(ダブルタイプ) 案内板 BK-666 P.280 掲示ボード BA-302 P.280 案内板 KAN-035 P.280 案内板 KAN-065 P.280 案内板 サインスタンド NRSS-450(BK) P.280 サインスタンド NRSS-450(SV) P.280 サインスタンド SSW-A4 P.281 サインスタンド SSW-B4 P.281 サインスタンド SSW-A3 P.281 サインスタンド KSW-A4 P.281 サインスタンド KSW-B4 P.281 サインスタンド KSW-A3 P.281 サインスタンド
アルミシリーズ
P.278 折畳み式傘立て
AS-27 P.279 傘立て AS-P9 P.279 アルミパネル式傘立て
FPS-100 P.279
パンフレット スタンド



NKBP-C204 P.282 NEW 掲示ボード付パンフレットスタンド NSP-102C P.282 サイン&パンフレットスタンド (A4)



NSP-C202 P.282 サイン&パンフレットスタンド (A3)



NDP-110 P.282 パンフレットスタンド NDP-210 P.282 パンフレットスタンド



NDP-310 P.282 パンフレットスタンド


KSL-C206 P.283 パンフレットスタンド


KSL-C306 P.283 パンフレットスタンド

パンフレットスタンド
KSL-C406 P.283

AS-PF30(BK/WH)
パンフレットスタンド(直立型)
P.284
マガジン スタンド
ベルト パーティション
記載台

NPC-C102 P.288 卓上パンフレットスタンド
KP-C105 P.283 パンフレットスタンド




KNM-330 P.285 マガジンスタンド

BP-3586ST P.287 ベルトパーティション

パンフレットスタンド
KP-C205 P.283

AS-PF10 P.284 パンフレットスタンド(直立型) AS-PF20 P.284 パンフレットスタンド(直立型)

KNM-340 P.285 マガジンスタンド

BP-3C P.287 三方向キャッチ

NUK-480 P.288 受付 記載台 NOPC P.288 NUK/NIF用パンフレットケース

NPC-C202 P.288 卓上パンフレットスタンド







KP-C305 P.283 パンフレットスタンド

NPF-C108 P.283 パンフレットスタンド

NPF-C208 P.283 パンフレットスタンド

NPF-C308 P.283 パンフレットスタンド

AS-PF30 P.284 パンフレットスタンド(直立型) AS-PF8N P.285 パンフレットスタンド(傾斜型) AS-PF12N P.285 パンフレットスタンド(傾斜型) AS-PF16N P.285 パンフレットスタンド(傾斜型)




KNM-350 P.285 マガジンスタンド

BP-SH P.287 サインホルダー

NUK-B P.288 記載台用掲示ボード


NFM-50(GM) P.285 マガジンスタンド(フロアタイプ) NFM-50(SV) P.285 マガジンスタンド(フロアタイプ)
PAN-11 P.286 マガジンスタンド



KK-120H P.288 記載台ハイタイプ








KK-90H P.288 記載台ハイタイプ KK-P120 P.288 記載台用掲示ボード
AS-PF10(BK/WH) P.284 パンフレットスタンド(直立型)

PAN-12 P.286 マガジンスタンド

KK-OP P.288 記載台プライバシーパネル (2枚組)









パンフレットスタンド(直立型)
AS-PF20(BK/WH) P.284

PLK-11 P.286 マガジンラック

NPC-C101 P.288 卓上パンフレットスタンド

 ホワイトボード
WBC-9045B P.290 NEW ミーティングボード
WBS-1209RF P.290 スチール両面ホワイトボード
WBS-1809RF P.290 スチール両面ホワイトボード WHP-912 P.290 ホーロー回転片面ホワイトボード WHP-R918 P.290 ホーロー回転両面ホワイトボード WUD-55B P.291 ミーティングボード
WUD-PT P.291 脱着式ペントレイ
WUD-GEL P.291 オプション ゲルチョーク (8本)
TUD-36Y P.291 透明ボード 横型
ホワイトボード
WBC-9045B P.290 NEW ミーティングボード
WBS-1209RF P.290 スチール両面ホワイトボード
WBS-1809RF P.290 スチール両面ホワイトボード WHP-912 P.290 ホーロー回転片面ホワイトボード WHP-R918 P.290 ホーロー回転両面ホワイトボード WUD-55B P.291 ミーティングボード
WUD-PT P.291 脱着式ペントレイ
WUD-GEL P.291 オプション ゲルチョーク (8本)
TUD-36Y P.291 透明ボード 横型
FW-635 P.292 予定表 (無地)
P.292 予定表 (行動予定)
P.292 予定表 (週予定) FW-M935 P.292 予定表 (月予定) WH-M912 P.292 月予定表・タテ書2段 WH-M456 P.292 月予定表・タテ書2段 WH-M918 P.292 月予定表・タテ書1段 WH-M918Y P.292 月予定表・ヨコ書2行 WH-M912Y P.292 月予定表・ヨコ書2行 WH-M456Y P.292 月予定表・ヨコ書2行 016 PHOTO INDEX インフォメーション スタンド
P.289 NEW 受付・モニタースタンド NUM-MT(BK/WH) P.289 NEW モニター取付金具
P.289 受付台
NR-2 P.289 新聞掛 NR-1 P.289 新聞掛
TUD-34Y P.291 透明ボード 横型 KMO-800 P.291 ミーティング用ボード (折畳み式)
KMB-700
P.291
ミーティング用ボード WH-345 P.292 ホーロータイプ WS-345
P.292 スチールタイプ
FW-A635
FW-W635
NUM-50
受付台 MUD-640
新聞掛
PH-5 P.289 ペーパーホルダー
掲示板







TWB-W912 P.293 木目柄ホワイトボード (壁掛タイプ) TKB-W918 P.293 木目柄掲示板(ピンマグ両用タイプ) TKB-W609 P.293 木目柄掲示板(ピンマグ両用タイプ) PMB-609 P.293 マグネットタイプ PMS-609 P.293 ピン・マグ両用タイプボード PBK-918 P.293 軽量ピンタイプ

PBK-912 P.293 軽量ピンタイプ

TBY-918 P.293 ピンレスタイプ
カウンター


HCT-1245 P.294 ハイカウンター HCT-945 P.294 ハイカウンター
ディスプレイ


NDS-100 P.295 ディスプレイスタンド NDS-SF1 P.295 棚板


















HCT-C445 P.294 ハイカウンター LCT-1460 P.294 ローカウンター LCT-760 P.294 ローカウンター




LCT-C600 P.294 ローカウンター































NDS-RR1 P.295 リモコンラック NDS-BP1 P.295 バックパネル
演台
NPT-WH
SPC-F12 P.296 折畳み演台 SPC-F8 P.296 折畳み演台 SPC-K12 P.296 演台 SPC-K9 P.296 演台 CMC-110 P.297 司会者台 NST-40
NPT-BK P.296 NEW 演台(プレゼンテーブル)
P.296 NEW 演台(プレゼンテーブル)
P.297 講演台 (昇降タイプ)
電話台 KTL-452
KU-75 P.297 サイドテーブル KNC-300L P.297 プリンタラック
コートハンガー HK-1200 P.298 コートハンガー
P.298 コートハンガー HK-1600B P.298 コートハンガー
電話台・ラック KTL-451 P.297
P.297 電話台
コートハンガー HK-900 P.298
HK-600B
ACH-1700 P.298 コートハンガー ACHHANGA P.298 オプションハンガー (黒・5本セット)
プランターハンガー G-SMG
ミックスグリーンS G-IB P.299 アイビー G-HIB P.299 斑入りアイビー G-MLL P.299 ミニリーフL
グリーンハンガー PHN-1200 P.299
P.299
G-MLGW P.299 ミニリーフG/W
T-30R
P.301 多目的スタンド T-30T
P.301 多目的スタンド
多目的スタンド VT-30B P.300 抗ウイルス多目的スタンド VT-45B P.300 抗ウイルス多目的スタンド
塗装(ローズ)
塗装(チーク)
T-30W
塗装(アイボリー) P.301 多目的スタンド
T-30N
メッキ(ナチュラル) P.301 多目的スタンド
T-30B
メッキ(ブラック) P.301 多目的スタンド T-45R 塗装(ローズ) P.301 多目的スタンド
多目的スタンド T-60B塗装(ブラック) P.301 多目的スタンド T-60Rメッキ(ローズ) P.301 多目的スタンド T-60Nメッキ(ナチュラル) P.301 多目的スタンド ダストボックス S-DB P.302 ダストボックス BTT-240 P.302 テーブルトラッシュ袋止め付 DB-1(BK/GR/SV) P.302 ダストボックス DB-2(BK/GR/SV) P.302 ダストボックス BKM-220(SV/WH) P.303 機密書類回収ボックス BKM-300(SV/WH) P.303 機密書類回収ボックス SK-1 P.303 スモーキングスタンド 017 PHOTO INDEX
T-45N塗装(ナチュラル) P.301
多目的スタンド
T-45Tメッキ(チーク) P.301 多目的スタンド T-45Wメッキ(アイボリー) P.301 多目的スタンド T-60W 塗装(アイボリー) P.301
スタンド
NDS-CS1 P.295 カメラスタンド
TBY-609 P.293
ピンレスタイプ
ベッド

EBD-B2(SV)+MR-80×2 P.304 2段ベッド



EBD-B2(SV)+ EBD-B2-OC+MR-80×2 P.304 2段ベッド(カーテン付)


EBD-B2-OS P.304 オプションサイドレール


MR-80 P.304 ウレタンマットレス


KBS-203+KBM-301(×2) P.305 スチール2段ベッド


KBS-203C+KBM-301(×2) P.305 スチール2段ベッド (カーテン付)


KBS-203R P.305 サイドレール


KBM-301 P.305 ウレタンマットレス

チップウレタンマットレス KBM-401L P.305 スタイロボードタタミ
KBM-302L P.305


KBS-212+KBM-302L(×2) P.306 スチール2段ベッド
KBS-212CG+KBM-401L(×2) P.306 スチール2段ベッド
KBS-212CB+KBM-401L P.306 スチール2段ベッド
KBS-202R P.306 KBS-212用サイドレール KBS-201LK P.306 KBS-212用床固定金具
KBS-103+KBM-301 P.306 スチール1段ベッド

オプション引き出し MRS-13 P.307 スプリングマット(シングル) EBD-02 P.308 イージーベッド
WBD-VHD P.307
バゲージラック

KLK-308 P.309 金庫


RKA-410 P.308 バゲージラック RKW-455 P.308 バゲージラック

KBES-2EH P.309 金庫


KBES-2 P.309 金庫


KLK-408-1 P.309 金庫




KOSS-D P.309 金庫 KOSS-E P.309 金庫 KOSS-F P.309 金庫

KOSS-C P.309 金庫

KLK-304 P.309 金庫



CoMbI 。 P.310 NEW 抗菌サークルボックス S-DB P.311 ダストボックス S-SB P.311 スクェアバスケット S-OB P.311 オーバルバスケット
ソファベッド

ZSB-1650 P.312 ソファベッド
ワゴン・脱衣カゴ

ZSB-1800 P.312 ソファベッド 診察台

WGN-3
木工










Y-OB P.312 折畳みベッド









S-LB
P.311・313
ランドリーボックス S-SK P.311 ストレージかご
P.313 ワゴン TDK-03 P.313 脱衣カゴ TDK-04 P.313 脱衣カゴ 抗菌手編み バスケット
金庫
WBD-V02 P.307 木製ベッド
抗ウイルス 学習デスク
GD-O7045
抗ウイルス学習デスク GD-S1200
抗ウイルス学習デスク専用仕切りパネル シェルフ
GD-P8060
P.318 抗ウィルス学習個別デスク
P.319
P.319
シェルフ
シェルフ
SHE-04 P.320
SHE-06 P.320
カウンター
グリーン
P.322 プランターハンガー G-SMG
ミックスグリーンS G-IB P.322 アイビー G-HIB P.322 斑入りアイビー G-MLL P.322 ミニリーフL G-MLGW P.322 ミニリーフG/W PPN-920 P.322 プランターアクリルパネル ASO-PB1530H P.323 NEW プランターボックス(ハイタイプ) 018 PHOTO INDEX
UNC-H1870T(WH) P.321 組立式ユニットカウンター UNC-H1570T(WH) P.321 組立式ユニットカウンター UNC-H1260T(BK) P.321 組立式ユニットカウンター
PHN-1200(MAK)
P.322

ASO-PB1530L
プランターボックス(ロータイプ)
P.323 NEW
記載台シリーズ
システムベンチ


ASO-SB1200R P.325 NEW システムベンチ


ASO-SB900S P.325 NEW システムベンチ



ハイカウンター シリーズ
ローカウンター シリーズ
受付カウンター シリーズ

VCH-ARW P.333
VKD-1250H P.327
抗ウイルス記載台 (ハイタイプ)
VKD-9050H P.327 抗ウイルス記載台 (ハイタイプ)
VKD-1250L P.327 抗ウイルス記載台 (ロータイプ)
VKD-9050L P.327 抗ウイルス記載台 (ロータイプ) VKDK-1250 P.327 抗ウイルス記載台 (掲示板付)






VHCT-1545
P.329
抗ウイルスハイカウンター VHCT-1245 P.329 抗ウイルスハイカウンター VHCT-845 P.329 抗ウイルスハイカウンター VHCT-C500 P.329 抗ウイルスハイコーナーカウンター VHCT-RS6050 P.329 抗ウイルスレジハイカウンター VTT-440 P.329 抗ウイルス手荷物台








抗ウイルスローカウンター VLCT-1270 P.331 抗ウイルスローカウンター VLCT-870 P.331 抗ウイルスローカウンター VLCT-C800 P.331 抗ウイルスローコーナーカウンター VLCT-KP1270 P.331 抗ウイルスローカウンター(片面パネル) VLCT-KP870 P.331 抗ウイルスローカウンター(片面パネル) VLCT-RP1270 P.331 抗ウイルスローカウンター(両面パネル)
VLCT-1570 P.331







VCH-UK P.332 抗ウイルス受付カウンター VCH-UKZ P.332 抗ウイルス受付カウンター増結セット
VCH-DE P.332 抗ウイルスデスクカウンター
VCH-DEZ P.332 抗ウイルスデスクカウンター増結セット VCH-SO P.333 抗ウイルス相談カウンター
VCH-SOZ P.333 抗ウイルス相談カウンター増結セット
VCH-RC P.333 抗ウイルスレジカウンター
VLCT-RP870 P.331 抗ウイルスローカウンター(両面パネル)

VCH-RCZ P.333 抗ウイルスレジカウンター増結セット

抗ウイルス飛沫ガードワイドパネル VCH-AR P.333 抗ウイルス飛沫ガードパネル








VWLT-1010


テーブル


VWLT-K9090 P.335
抗ウイルス昇降式 テーブル (片脚キャスター脚)

VWLT-K9060 P.335
抗ウイルス昇降式 テーブル (片脚キャスター脚)

VWLT-W1010 P.335
抗ウイルス昇降式 テーブル (キャスター脚)

VWLT-W9090 P.335
抗ウイルス昇降式 テーブル (キャスター脚)

抗ウイルス昇降式 テーブル (キャスター脚)
VWLT-W9060 P.335



VMRT-1890 P.336
抗ウイルス昇降式 テーブル



VMRT-K1890 P.336
抗ウイルス昇降式 テーブル (片脚キャスター脚)


VMRT-W1890 P.336
抗ウイルス昇降式 テーブル (キャスター脚)


VHAJ-K1690 P.337
抗ウイルスハイアジャスター テーブル


VHAK-K1290 P.337
抗ウイルスハイアジャスター テーブル (片脚キャスター脚)

VHAC-1590 P.337
抗ウイルスハイアジャスター テーブル (キャスター脚)

VFTR-1890N P.338
抗ウイルス 福祉用テーブル
 VFTR-1590N P.338
抗ウイルス福祉用 テーブル
VRK-F1890 P.339
抗ウイルス跳ね上げ式 昇降機能付テーブル
VRK-F1690 P.339
抗ウイルス跳ね上げ式 昇降機能付テーブル
VTM-1690 P.340
抗ウイルス跳ね上げ式
VFTR-1590N P.338
抗ウイルス福祉用 テーブル
VRK-F1890 P.339
抗ウイルス跳ね上げ式 昇降機能付テーブル
VRK-F1690 P.339
抗ウイルス跳ね上げ式 昇降機能付テーブル
VTM-1690 P.340
抗ウイルス跳ね上げ式
テーブル TM-1890 P.340 跳ね上げ式テーブル
P.342 カフェテーブル ASO-CF750W P.342 カフェテーブル 木製チェア MC-620NA P.343 木製チェア MC-620BR P.343 木製チェア MC-840NA P.344 木製チェア MC-840BR P.344 木製チェア MC-510NA P.345 木製チェア MC-510BR P.345 木製チェア DC-530P P.346 ダイニングチェア (肘付) DC-730P P.346 ダイニングチェア
VWST-9055 P.341 抗ウイルス昇降式テーブル
カフェテーブル ASO-CF750B
(肘付) 福祉用テーブル
P.335 抗ウイルス昇降式 テーブル
VWLT-9090 P.335 抗ウイルス昇降式 テーブル VWLT-9060 P.335 抗ウイルス昇降式
019 PHOTO INDEX
福祉







ダイニングチェア (肘なし)
DC-430P P.346
ラウンジソファ
ラウンジベンチ
FC-670P P.347 折畳みチェア

FC-570P P.348 折畳みチェア

LS-600N P.351 ラウンジソファ LS-600S P.351 ラウンジソファ


WC-2P P.349 木製チェア
座位サポート ベンチ

ASO-WC2F-NA P.350 木製チェア

SPB-600W P.352 座位サポートベンチ

ASO-WC2T(NA) P.350 木製チェア ASO-WC1(BL) P.350 木製チェア

SPB-1800W P.352 座位サポートベンチ








ハンドレールス テッキⅡ

WB5135 P.360


Twin
背上式ベッド







かるがも® 4ポイント ステッキ
WB3826 P.361
かるがも®4ポイントステッキ

WB3882






















LO1B P.353 ラウンジベンチ LO1W P.353 ラウンジベンチ LO2B P.353 ラウンジベンチ LO2W P.353 ラウンジベンチ LO2TW P.353 ラウンジベンチ(天板付) L02TB P.353 ラウンジベンチ(天板付) LO3B P.353 ラウンジベンチ LO3W P.353 ラウンジベンチ
P.355
WG-51 P.356 シャワーチェア WG-53
シャワーチェア WE-SC1
NEW シャワーチェア
P.356 シャワーチェア
KTB-1498 P.357 背上式MCベッド KTB-1165 P.357 HAマットレス アルミ製 自走式車イス WE-K1 P.358 アルミ製自走式車イス
昇降式手すり WE-CT5050+ WE-CT5050-MAT-A P.359 昇降式手すり
WE-CT5050 P.359 昇降式手すり WE-CT5050-MAT-A P.359 昇降式手すり用マット
ハンドレールステッキⅡブーケ WB5134 P.360 ハンドレールステッキⅡブラック
Z StickⅡ WB5240 P.361 TWin Z Stick Ⅱ WB5238 P.361 TWin Z Stick Ⅱ WB5239 P.361 TWin Z Stick Ⅱ
伸縮ステッキ
WB3827 P.361 かるがも®4ポイントステッキ WB3828 P.361 かるがも®4ポイントステッキ フラミンゴN
P.361
WB3883 P.361 フラミンゴN伸縮ステッキ WB3884 P.361 フラミンゴN伸縮ステッキ WB3885 P.361 フラミンゴN伸縮ステッキ WB3886 P.361 フラミンゴN伸縮ステッキ WB5212 P.361 フラミンゴN伸縮ステッキ KSC-K20 P.366 クッション KSC-K30 P.366 クッション KSC-C1150 P.366 マット KSC-I250 P.366 マット 幼保 手編みカゴ S-SK P.363 ストレージかご S-SB P.363 スクェアバスケット S-OB P.363 オーバルバスケット S-DB P.363 ダストボックス 絵本ラック ENR-O P.364 絵本ラックオープン ENR-S P.364 絵本ラックスタンド ENR-K P.365 絵本ラックkumiki KUMI-350H P.365 箱 KUMI-350F P.365 クッションPVC張り スツール クッション マット KSC-1150 P.366 スツール (大) KSC-900 P.366 スツール (小) KSC-B925 P.366 シューズBOX KSC-K10 P.366 クッション 020 PHOTO INDEX
フラミンゴN伸縮ステッキ



マット
KSC-M90 P.366

AG-WM P.368 ウォールマット
園児用ベンチ
抗ウイルス テーブル
AG-RS1200 P.367 スツール (サイド・コーナー)
AG-SS950 P.367 スツール (サイド・コーナー)

KE-WM P.368 NEW ウォールマット

ENB-1200 P.369 園児用ベンチ

ENT-K330V P.370 スタックテーブル角
キッズ ソファベッド

ENT-D330V P.370 スタックテーブル台形

AG-KMA P.367 クッション


AG-KSA P.367 クッション AG-KSI P.367 クッション



AG-MAS P.367 マット
AG-SAS P.367 マット

K-SOB P.369 キッズソファベッド

ENT-1260V P.370 5段階テーブル
園児用イス

ENC-250 P.372 学習イス
レンタル・リース

樹脂テーブル

CB-T-1845 P.372 ブロー成型テーブル用天板



ENT-9060V P.370 5段階テーブル
FC-1260 P.371 折畳みテーブル
FCK-1260 P.371 折畳みテーブル




CBT-1845S P.372 ブロー成型テーブル (スライド脚) CBT-1845C P.372 ブロー成型テーブル (クランク脚) CBT-1845B P.372 ブロー成型テーブル (バネ脚) CBT-1845U P.372 ブロー成型テーブル (薄型脚)
AG-SMA P.367 マット

BT-1860B P.373 ブロー成型テーブル
アルミ折畳み 樹脂イス


BT-1860S P.373
ブロー成型テーブル
会議テーブル

GTA-A1260SSE P.375 合板芯折畳み薄型アルミ脚テーブル



GTS-1860SSE P.374

GTA-A1245BSE P.375 合板芯折畳み薄型アルミ脚テーブル


アルミ折畳みイス (クッションパット付)
AFC-2APU P.373

合板芯折畳み薄型スチール脚テーブル GTS-1845BSE P.374
合板芯折畳み薄型スチール脚テーブル

AZT-1860SU P.376 上げ底天板テーブル


YKT-TN1260SUSE P.379 折畳み会議テーブル
AFC-2A P.373 アルミ折畳みイス






合板芯折畳み薄型スチール脚テーブル GTS-A1860BSE P.374
GTS-9060BSE P.374

AZT-1845BU P.376


合板芯折畳み薄型アルミ脚テーブル GTS-A1845SSE P.374 合板芯折畳み薄型アルミ脚テーブル






GTA-1860SSE P.375
合板芯折畳み薄型スチール脚テーブル



VKT-TN1845SSSE P.380 抗ウイルス折畳み会議テーブル VKT-1860BSSE P.380 抗ウイルス折畳み会議テーブル VKT-TN1890GCSE P.380 抗ウイルス折畳み会議テーブル VKT-TN1560SCSE P.380 抗ウイルス折畳み会議テーブル
GTA-1845BSE P.375
合板芯折畳み薄型スチール脚テーブル



GTA-9060BSE P.375
合板芯折畳み薄型スチール脚テーブル



VKT-TN1260BBSE P.381 抗ウイルス折畳み会議テーブル VKT-TN9045SBSE P.381 抗ウイルス折畳み会議テーブル
021 PHOTO INDEX
上げ底天板テーブル
上げ底天板テーブル
上げ底天板テーブル
AZT-1860BS P.376 上げ底天板テーブル AZT-1845SS P.376 上げ底天板テーブル AZT-1560BS P.376
AZT-1845SS P.376
PNT-1860S P.377 パネコートテーブル
パネコートテーブル VNT-1860
ベニヤテーブル
P.377 ベニヤテーブル OKT P.377 テーブル用オプション継脚 YKT-TN1845SSSE P.378 折畳み会議テーブル YKT-TN1860BSSE P.378 折畳み会議テーブル YKT-TN1890GCSE P.378 折畳み会議テーブル YKT-TN1560SCSE P.378 折畳み会議テーブル YKT-TN9045BBSE P.379 折畳み会議テーブル YKT-TN1260SBSE P.379 折畳み会議テーブル YKT-TN9060BUSE P.379 折畳み会議テーブル
PNT-1845S P.377
P.377
VNT-1845









抗ウイルス折畳み会議テーブル VKT-TN9060BUSE P.381 抗ウイルス折畳み会議テーブル SO-1860S P.382 一体成型天板テーブル SO-1845B P.382 一体成型天板テーブル SO-1860BB P.382 一体成型天板テーブル SO-1845SB P.382 一体成型天板テーブル STO-1860 P.382 一体成型天板テーブル STO-1845B P.382 一体成型天板テーブル OTC-1860SSE P.383 昇降機能付アルミ折畳会議テーブル
VKT-TN1260SUSE P.381


昇降機能付アルミ折畳会議テーブル KG-1845 P.383 昇降機能付折畳み会議テーブル
OTC-1845BSE P.383
抗ウイルス カフェテーブル







SI-5050(NA)+ROU-4060T P.384 抗ウイルスカフェテーブル SI-4545(DBR)+ROU-3676M P.384 抗ウイルスカフェテーブル SI-6565(WH)+ROU-4560T P.384 抗ウイルスカフェテーブル MR-750(NA)+ROU-4560T P.384 抗ウイルスカフェテーブル MR-550(DBR)+ROU-3676M P.384 抗ウイルスカフェテーブル MR-650(WH)+ROU-4060T P.384 抗ウイルスカフェテーブル







SI-7575(WH)+JEE-6638T P.385 抗ウイルスカフェテーブル

SI-7575(DBR)+JEE-6638M P.385 抗ウイルスカフェテーブル MR-850(WH)+JEE-6638T P.385 抗ウイルスカフェテーブル MR-850(NA)+JEE-6638M P.385 抗ウイルスカフェテーブル MR-900(DBR)+JEE-7638T P.385 抗ウイルスカフェテーブル SI-5555(NA)+RYS-4038T P.386 抗ウイルスカフェテーブル SI-6060(WH)+RYS-4538M P.386 抗ウイルスカフェテーブル MR-700(NA)+RYS-4538M P.386 抗ウイルスカフェテーブル MR-650(DBR)+RYS-4038T P.386 抗ウイルスカフェテーブル

SI-7070(DBR)+RSC-5060M P.387 抗ウイルスカフェテーブル
組立式 ユニット カウンター
折畳み 受付カウンター


MR-750(NA)+RSC-5060M P.387 抗ウイルスカフェテーブル MR-750(NA)+RSC-5060M P.387 抗ウイルスカフェテーブル



UNC-H1870T(WH) P.388 組立式ユニットカウンター
UNC-H1570T(WH) P.388 組立式ユニットカウンター
UNC-H1260T(BK) P.388 組立式ユニットカウンター

UC-900(WH) P.389 折畳み受付カウンター
折畳みイス

UC-900(BK) P.389 折畳み受付カウンター スタンド カウンター












UNC-L1870T(WH) P.388 組立式ユニットカウンター UNC-L1570T(WH) P.388 組立式ユニットカウンター UNC-L1260T(BK) P.388 組立式ユニットカウンター


SCT-6545(BK) P.389 スタンドカウンター SCT-6545(WH) P.389 スタンドカウンター












SI-8585(NA)+JEE-7638T P.385 抗ウイルスカフェテーブル

SI-6060(WH)+RSC-4560M P.387 抗ウイルスカフェテーブル


022 PHOTO INDEX
SFC-2T P.390 折畳みイス
SFC-2M P.390 折畳みイス
FP-930 P.390 折畳みイス
SFC-2BS P.390 SFC-2用背板
SFC-2ST P.390 SFC-2用座板
チェア
レセプション チェア/ 台車 MMR-2M P.390 レセプションチェア MMR-2HM P.390 レセプションチェア MMP-73 P.390 チェア台車 スタッキング
MK-480 P.391 マッキンリー MACZB P.391 マッキンリーレザー背表 MACZA
P.391
マッキンリーレザー座 MEO-305
P.391
メモ台
SC-20 P.392 ミーティングチェア スツール 丸イス P.392 丸イス HM-320 P.392 木座スツール RMS-345B
リング付丸スツール RMS-345S
ラウンジスツール
ROB-1800 P.393 折畳みベンチ ROB-1500 P.393 折畳みベンチ 診察台 SSD-1860 P.393 診察台 SSD-1860ST
ミーティング チェア
P.392
P.392 リング付丸スツール ラウンジスツール RST-380 P.393
折畳みベンチ
P.393 診察台 (サイドレール付)
折畳カラーベンチ





アルミ折畳ベンチ
アクリルパネル
ステージ台
演説台・ 司会者台
宴会テーブル

ETZ-K1860 P.398 フライト式宴会テーブル
コートハンガー
アルミベルト パーティション
折畳カラーベンチ
FB-3S P.394

AFB-1S
バネ脚折畳みアルミベンチ (背なし)
P.394

SMP-1809AR
FB-4S P.394 折畳カラーベンチ
木製ベンチ

マグネットパーティション SMP-FK P.395 SMP安定脚 (キャスター脚)
P.395


折畳式ステージ台
STG-400B P.396

EDA-1200 P.397 折畳み演説台

ET-900R P.398 宴会テーブル(円型)
食器棚

HK-600 P.399 コートハンガー

ABP-BK P.400 アルミベルトパーティション
STG-400G P.396 折畳式ステージ台


ET-1200R P.398 宴会テーブル(円型)

SDP-1800 P.399 食器棚

HK-900 P.399 コートハンガー

ABP-SV P.400 アルミベルトパーティション
BENTIITA18BL P.394
カラ−ベンチ用座・背板 BENTIKR P.394 カラ−ベンチ用キャップ (右) BENTIKL P.394 カラ−ベンチ用キャップ (左)

MB-1830 P.394 木製ベンチ

SMP-F P.395 SMP安定脚 (アジャスター脚)


MB-1530 P.394 木製ベンチ
三ツ折衝立

楢 -88(ホワイト) P.395 三ッ折衝立

楢 -66(アイボリー) P.395 三ッ折衝立

STP-HO P.395 楢補強脚


ATPS-246AL P.396 アルミポータブルステージ ANSS-400AL P.396 アルミステップ ANSS-200AL P.396 アルミステップ
SKD-6045 P.397 司会者台 屏風

TT-900 P.398 ターンテーブル
ホワイトボード

HK-1200B P.399 コートハンガー




ANSS-100AL P.396 アルミステップ ANSC-2 P.396 ステージ用スカート (1m当り)

FSL-66 P.397 屏風 VSL-68 P.397 抗ウイルス屏風 FBK-6 P.397 屏風ケース




ET-1800RH P.398 宴会テーブル(半円型) ET-1500RH P.398 宴会テーブル(半円型) ET-1890 P.398 宴会テーブル(長方形) ET-0909 P.398 宴会テーブル(長方形)

WBS-1809RF P.399 スチール両面ホワイトボード


HK-1600B P.399 コートハンガー ACHHANGA P.399 オプションハンガー (黒・5本セット)
インスタント ポール
ISP-1833 P.401 インスタントポール ISP-1950 P.401 インスタントポール
チェーン パーティション

ETZ-1200 P.398 フライト式宴会テーブル

OCP-1G P.400 チェーンパーティション
023 PHOTO INDEX
SOCIA

Chair
Desk / Storage
Partition
Reception
Lobby
Exterior
ASO-CTB(BL)
ASO-CF1260B(BR)
024
ASO-LS600N(BL)
SOCIA
チェア
デスク・収納
パーティション
テーブル
レセプション
Table
ロビー
エクステリア
アクセサリー
Accessories
カフェ感覚で働く場所も働き方も自由にコーディネイト。
そんな心地よいオフィスづくりをサポートします。
一人ひとりに働き心地が良く、自然と集まりたくなるオフィスのカタチを提案します。
各スタイルに合わせて目線を変え、気分を変え、リビングのようなカジュアルなアイテムでワークシーンを彩ります。

SIAA(抗菌製品技術協議会)とは 適正で安心できる抗菌・防カビ・抗ウイルス加工製品 の普及を目的とし、抗菌剤・防カビ剤・抗ウイルス剤お よび抗菌・防カビ・抗ウイルス加工製品のメーカー、試 験機関が集まってできた団体です。
※詳細につきましてはP002を 参照ください。
ASO-CT1845B(NA)
PHN-1200(MAK)
ASO-LS600S(PK)
025

柔軟なワークスペースで良いアイデアの きっかけをサポートします。
カフェのような開放的な コミュニケーション空間
ぬくもりを感じる木調のアイテムで ナチュラルな雰囲気が、創造性やいやし効果を演出します。
 ASO-CF750B(SGR)
ASO-WC2F-NA(GJ)
ASO-CTB(LGN)
ASO-WH1811B(MAK)
ASO-CTB(BL)
ASO-CF750B(SGR)
ASO-WC2F-NA(GJ)
ASO-CTB(LGN)
ASO-WH1811B(MAK)
ASO-CTB(BL)
026
PPN-920(MAK)




 ASO-CF750W(NA)
ASO-L01B(PK)
ASO-WC1(IV)
ASO-CF750W(NA)
ASO-L01B(PK)
ASO-WC1(IV)
ASO-LS600N(BL)
ASO-CF1260B(BR)
ASO-L01B(BL) 027
ASO-CT1845B(NA)
カフェでくつろぐ感覚でオフィスワークをサポートします。

 ASO-HCT1845B(NA)
ALES-CTB(NA)
ASO-CF7575B(NA)
ASO-PT1211RH(NA)
ASO-WC1(BL)
ASO-HCT1845B(NA)
ASO-S9045B(NA)
ALES-CTB(NA)
ASO-HCT1845B(NA)
ALES-CTB(NA)
ASO-CF7575B(NA)
ASO-PT1211RH(NA)
ASO-WC1(BL)
ASO-HCT1845B(NA)
ASO-S9045B(NA)
ALES-CTB(NA)
028




 ASO-CF750B(NA)
ASO-CT1845B(NA)
ASO-WC2F-NA(MS)
ASO-M1575W(MAK)
ASO-WC2T(NA)
ASO-CF750B(NA)
ASO-CT1845B(NA)
ASO-WC2F-NA(MS)
ASO-M1575W(MAK)
ASO-WC2T(NA)
ASO-CF750B(NA) ALES-CTB(BR) 029
ASO-PT1271KH(BR)

オフィスの中心となるエリア 出社人数に対応し、ゆとりの空間、集中エリアを展開できます。
黒の集中ワーク、 白のリラックスワーク 天板はホワイト、ナチュラル・ミディアム・ ブラウンウッド調でフレームは柔らかいホワイト、 精悍なブラックでオフィスを演出します。
 ASO-W2411B(MAK)
ASO-OC1(BL)
ASO-LS600N(LGN)
PRO-4W(NA)
ASO-WC2T(NA)
ASO-W2411W(NA)
ASO-S9060B(MAK)
ASO-W2411B(MAK)
ASO-OC1(BL)
ASO-LS600N(LGN)
PRO-4W(NA)
ASO-WC2T(NA)
ASO-W2411W(NA)
ASO-S9060B(MAK)
030


 ASO-CF1260W(BR)
ASO-LS600S(PK)
ASO-CF6060W(NA)
ASO-SP1B(NV)×2
ASO-SP3B(GR)×1
ASO-LS600S(BJ)
ASO-OC1(GR)
ASO-CF1260W(BR)
ASO-LS600S(PK)
ASO-CF6060W(NA)
ASO-SP1B(NV)×2
ASO-SP3B(GR)×1
ASO-LS600S(BJ)
ASO-OC1(GR)
ALES-CTB(BR) 031
ASO-WH1811B(MAK)


 ASO-HCT1845B(MAK)
ASO-W2411B(MAK)
CKH11(BK)+CKH11-AR
PRO-4W(NA)
ASO-WC2T(NA)
ASO-W2411W(NA)
ALES-CT(NA)
ASO-L01W(PK) ASO-L02TW(PK) ASO-WH1811W(MAK)
ASO-HCT1845B(MAK)
ASO-W2411B(MAK)
CKH11(BK)+CKH11-AR
PRO-4W(NA)
ASO-WC2T(NA)
ASO-W2411W(NA)
ALES-CT(NA)
ASO-L01W(PK) ASO-L02TW(PK) ASO-WH1811W(MAK)
032
ASO-S9045B(MAK)
周囲や感染症に配慮した集中ワークスタイル。
幕部の布は抗ウイルス仕様です。



 ASO-OC1(GR)
ASO-WT6050B(MAK)
ASO-SP1B(GR)×2
ASO-OC1(GR)
ASO-ST400B(MAK)
ASO-SP3W(GR)
ASO-SP1W(GR)
ASO-SP3B(GR)×1
ASO-SP1B(NV)×2
ASO-LS600S(LGN)
ASO-LS600S(BJ)
ASO-SP3W(NV)
ASO-SP3W(GR)
ASO-OC1(GR)
ASO-WT6050B(MAK)
ASO-SP1B(GR)×2
ASO-OC1(GR)
ASO-ST400B(MAK)
ASO-SP3W(GR)
ASO-SP1W(GR)
ASO-SP3B(GR)×1
ASO-SP1B(NV)×2
ASO-LS600S(LGN)
ASO-LS600S(BJ)
ASO-SP3W(NV)
ASO-SP3W(GR)
033

木の温もりが感じられる
開放的な空間を演出します。
リビング感覚でリラックス空間に調和する ミーティング
ミーティング、リフレッシュスペース、グループワークなど 多様なシーンで活躍するミーティングテーブルです。
 ASO-OC1(BL)
ASO-OC1(GN)
ASO-M1575W(MAK)
PHN-1200
ASO-OC1(BL)
ASO-OC1(GN)
ASO-M1575W(MAK)
PHN-1200
034


 G-TP2+G-TP1
ASO-CF750B(NA)
ASO-WC2F-NA(GJ)
ASO-CF1260W(MAK)
ASO-WC1(BL)
G-TP2+G-TP1
ASO-CF750B(NA)
ASO-WC2F-NA(GJ)
ASO-CF1260W(MAK)
ASO-WC1(BL)
035
ASO-WC2T(NA)
活発な意見交換と最適な判断、決定の場に。


 ASO-S9045B(BR)
ALES-HP-FMS-B
ASO-HC320C(WN)
ASO-HC320C(GR)
ASO-M1890B(BR)
ASO-OC1(GN)
ASO-M1575B(BR)
ASO-S9045B(BR)
ALES-HP-FMS-B
ASO-HC320C(WN)
ASO-HC320C(GR)
ASO-M1890B(BR)
ASO-OC1(GN)
ASO-M1575B(BR)
036



ASO-WC2F-NA(MS)
ASO-WC2F-NA(GJ)
ASO-WC2T(NA)
ASO-CF7575B(NA)
ASO-OC1(GN)
037
ASO-M1575B(BR)
くつろぎのひと時やライトワークにも応えます。

ゆったりとしたコミュニケーションワーク 自由自在なレイアウトで創造性豊かなソファワークを サポートします。リラックスするだけでなくミーティング、 ソロワーキングも行えます。
 ASO-LS600N(LGN)
ASO-CF750W(MAK)
ASO-LS600N(LGN)
ASO-CF750W(MAK)
038
ASO-LS600N(LGN)


 ASO-CF 6060W (WH)
ASO-CF1040W(NA)
ASO-LS600N(BL)
ASO-CF1260W(NA)
ASO-CF 6060W (WH)
ASO-CF1040W(NA)
ASO-LS600N(BL)
ASO-CF1260W(NA)
039
ASO-LS600S(BL)
コミュニケーションワークや簡単なソロワークにも調和します。


 ASO-L02W(PK)
ASO-CF1260B(BR)
ASO-L01B(LGN)
ASO-L02B(PK)
ASO-L02W(PK)
ASO-CF1260B(BR)
ASO-L01B(LGN)
ASO-L02B(PK)
ASO-OT1260(MAK)
PHN-1200
040
LKC-580(IV)




 ASO-CF6060W(MAK)
ASO-L01W(BR)
ASO-CF1040B(MAK)
ASO-L02B(BL)
ASO-L01W(LGN)
ASO-L02TW(BR)
ASO-CF1260W(BR)
ASO-L01B(BR)
ASO-L02TB(BR)
G-TP2+G-TP1
ASO-PB1530L(NA)
ASO-BLS(LGR)
ASO-CF6060W(MAK)
ASO-L01W(BR)
ASO-CF1040B(MAK)
ASO-L02B(BL)
ASO-L01W(LGN)
ASO-L02TW(BR)
ASO-CF1260W(BR)
ASO-L01B(BR)
ASO-L02TB(BR)
G-TP2+G-TP1
ASO-PB1530L(NA)
ASO-BLS(LGR)
041
ASO-OT1260(MAK)
Work table
ASO-HCT1845B(NA)
ASO-W2411B(MAK)

ASO-W1111B (BR)


CKH11(BK)




ASO-S9045B(MAK)
レイアウトが容易で、使い勝手が良い 奥行1100㎜の天板サイズを採用しました。
■SOCIAシリーズ天板カラーサンプル






WH:ホワイト NA:ナチュラル MAK:ミディアムオーク BR:ブラウン 配線ホール

ASO-W1111W (NA)
仕様/天板:抗ウイルスメラミン化粧板 (t22mm) フラッシュ加工 抗ウイルスABSエッジ(SGRは通常ABS) 天板裏:抗ウイルスバッカ- 脚:スチール 粉体塗装(B・ブラック、W・ホワイト) 入数:1(3個口)

ASO-W1811B(SGR)

ASO-W1811W (BR)
ワークテーブル 価格(税抜) サイズ(mm) 梱包才数梱包重量
ASO-W1811B 147,000円 W1800×D1100×H720
ASO-W1811W 147,000円 W1800×D1100×H720
▲ 14.3才49.9kg
▲ 14.3才49.9kg
仕様/天板:抗ウイルスメラミン化粧板 (t22mm) フラッシュ加工 抗ウイルスABSエッジ(SGRは通常ABS) 天板裏:抗ウイルスバッカ- 脚:スチール 粉体塗装(B・ブラック、W・ホワイト) 入数:1(3個口)

ASO-W2411B (MAK)

ASO-W2411W (NA)
ワークテーブル 価格(税抜) サイズ(mm) 梱包才数梱包重量
ASO-W2411B 170,000円 W2400×D1100×H72012.9才 62.3kg
ASO-W2411W 170,000円 W2400×D1100×H72012.9才 62.3kg
仕様/天板:抗ウイルスメラミン化粧板 (t22mm) フラッシュ加工 抗ウイルスABSエッジ(SGRは通常ABS) 天板裏:抗ウイルスバッカ- 脚:スチール 粉体塗装(B・ブラック、W・ホワイト) 入数:1(4個口)

SGR:ストーングレー

ASO-W1111W (WH)
ASO-W1111B/W

ASO-W1811W (NA)
ASO-W1811B/W

ASO-W2411W (WH)
ASO-W2411B/W
637 878 1100 1100 840 720 656 637 878 1100 1800 1540 720 656 637 878 1100 2400 2140 720 656 ワークテーブル 価格(税抜) サイズ(mm) 梱包才数梱包重量 ASO-W1111B 114,000円 W1100×D1100×H72012.5才 38.8kg ASO-W1111W 114,000円 W1100×D1100×H72012.5才 38.8kg
042
High Work table
ASO-S9045B(BR)
ALES-CTB(BR)

ASO-WH1811B(NA)






ASO-WH1811B(MAK)

ASO-WH1811B(BR)
(t22mm) フラッシュ加工 抗ウイルスABSエッジ(SGRは通常ABS) 天板裏:抗ウイルスバッカ- 脚:スチ-ル 粉体塗装 (ブラック) 入数:1(4個口)



落ち着いた空間を演出する ブラックフレーム

ASO-WH1811B(WH)

空間を明るく演出する ホワイトフレーム


ASO-WH1811W 203,000円 W1800×D1100×H1000
▲ 15.7才66.6kg 仕様/天板:抗ウイルスメラミン化粧板 (t22mm) フラッシュ加工
抗ウイルスABSエッジ(SGRは通常ABS) 天板裏:抗ウイルスバッカ- 脚:スチ-ル 粉体塗装 (ホワイト) 入数:1(4個口)
618 758 1100 1800 1540 1000 544 500 21 8 1610 618 758 1100 1800 1540 1000 544 500 21 8 1610
価格(税抜) サイズ(mm) 梱包才数梱包重量 ASO-WH1811B 203,000円 W1800×D1100×H1000 ▲ 15.7才66.6kg 仕様/天板:抗ウイルスメラミン化粧板
ワークテーブル
ワークテーブル 価格(税抜) サイズ(mm) 梱包才数梱包重量
ASO-WH1811B(MAK)
ASO-WH1811W(WH)
ASO-WH1811W(NA)
ASO-WH1811W(BR)
ASO-WH1811W(MAK)
ASO-WH1811
ASO-WH1811
ASO-WH1811W(NA)
ALES-CT(NA)
043 SOCIA
チェアデスク・収納パーティションテーブルレセプションロビーエクステリアアクセサリー木工 幼保レンタル・リース
Meeting Table






モニターやホワイトボードを使用した打ち合わせ、 プレゼン等に最適な台形ミーティングテーブル。
正面からの位置をずらして座ることで死角が少なくなり、参加者全員が見えやすくなります。
ASO-DT
■SOCIAシリーズ天板カラーサンプル

BR:ブラウン





仕様/天板:抗ウイルスメラミン化粧板 (t22mm) 抗ウイルスABSエッジ(SGRは通常ABS) 天板裏:抗ウイルスバッカ- 本体:メラミン化粧板 脚:スチ-ル 粉体塗装 (ブラック) 入数:1(3個口)



400 900 698 750 720 1500/1200 500/300 750 900
170,000円 W1500×D900×H7204.8才 48.4kg
165,000円 W1200×D900×H7204.6才 39.4kg
ミーティングテーブル 価格(税抜) サイズ(mm) 梱包才数梱包重量 ASO-DT1590B
ASO-DT1290B
ASO-DT1290B(BR)
ASO-DT1290B(MAK)
ASO-DT1290B(NA)
ASO-DT1590B/1290B
ASO-DT1290B(WH)
YSC01(GN)
ASO-DT1590B(WH)
NDS-100(BK)
WH:ホワイト NA:ナチュラル MAK:ミディアムオーク
SGR:ストーングレー
044





ミーティングやカフェなどさまざまな シーンに合わせられるテーブル。





900/750
1800/1500
1638/1338
1764/1464 720
仕様/天板:抗ウイルスメラミン化粧板(22mm厚)フラッシュ加工 抗ウイルスABSエッジ(SGRは通常ABS) 天板裏:抗ウイルスバッカー 脚:スチール 粉体塗装(ブラック) 入数:1(2個口)
ASO-OC1
700







多彩な使い方が可能な


ASO-M1575B(NA)
ミーティングテーブル 価格(税抜)サイズ(mm)梱包才数梱包重量 ASO-M1575B/W 88,000円 W1500×D750×H7205.7才28.9kg
仕様/天板:抗ウイルスメラミン化粧板 (t22mm) フラッシュ加工 抗ウイルスABSエッジ(SGRは通常ABS) 天板裏:抗ウイルスバッカ- 脚:スチ-ル 粉体塗装 (ブラック) 入数:1(3個口)


900/750
1800/1500
ミーティングテーブル 価格(税抜)サイズ(mm)梱包才数梱包重量
ASO-M1890B/W 98,000円 W1800×D900×H720 ▲ 7.0才33.9kg 仕様/天板:抗ウイルスメラミン化粧板 (t22mm) フラッシュ加工 抗ウイルスABSエッジ(SGRは通常ABS)
天板裏:抗ウイルスバッカ- 脚:スチ-ル 粉体塗装 (ブラック) 入数:1(3個口)
1728/1428
720
ASO-M1890/1575
828/678
657
625
ASO-T1575B(SGR)
KRM-430G(BL)
ASO-BLS(IV)
ASO-T1575B(NA)
ASO-S9045B(MAK)
ASO-M1890B(BR)
ASO-OC1(GN)
(GR)
ASO-T1575B(BR)
ASO-T1575B(MAK)
ASO-M1890W(BR)
ASO-M1890W(NA)
ASO-M1890W(WH)
ASO-T1575B(SGR)
Meeting table Table
4本ワイド脚のシャープなミーティングテーブルです。
テーブル 価格(税抜) サイズ(mm) 梱包才数梱包重量 ASO-T1890B 99,000円 W1800×D900×H720 7.3才 ▲ 31.2kg ASO-T1575B 91,000円 W1500×D750×H720 5.6才 26.5kg
045 SOCIA チェアデスク・収納パーティションテーブルレセプションロビーエクステリアアクセサリー木工
ASO-M1575B(MAK)
幼保レンタル・リース
Counter table














カウンターテーブル 価格(税抜) サイズ(mm)梱包才数梱包重量
ASO-CT1845B 82,000円 W1800×D450×H7205.3才35.8kg
ASO-CT1845W 82,000円 W1800×D450×H7205.3才35.8kg 仕様/天板:抗ウイルスメラミン化粧板 (t22mm) 抗ウイルスABSエッジ(SGRは通常ABS) 天板裏:抗ウイルス バッカ- 脚:スチ-ル 粉体塗装 (B・ブラック、W・ホワイト) 入数:1(3個口)
High Counter table

カウンターテーブル (幕板付) 価格(税抜) サイズ(mm)梱包才数梱包重量
ASO-CT1845MB 115,000円 W1800×D450×H7206.5才40.8kg
ASO-CT1845MW 115,000円 W1800×D450×H7206.5才40.8kg
仕様/天板:抗ウイルスメラミン化粧板 (t22mm) 抗ウイルスABSエッジ(SGRは通常ABS) 天板裏:抗ウイルス バッカ- 脚:スチ-ル 粉体塗装 (B・ブラック、W・ホワイト) 入数:1(4個口)



カウンターテーブル 価格(税抜) サイズ(mm)梱包才数梱包重量
ASO-HCT1845B 89,000円 W1800×D450×H10006.7才38.2kg
ASO-HCT1845W 89,000円 W1800×D450×H10006.7才38.2kg
仕様/天板:抗ウイルスメラミン化粧板 (t22mm) 抗ウイルスABSエッジ(SGRは通常ABS) 天板裏:抗ウイルス バッカ- 脚:スチ-ル 粉体塗装 (B・ブラック、W・ホワイト) 入数:1(3個口)







カウンターテーブル (幕板付) 価格(税抜) サイズ(mm)梱包才数梱包重量
ASO-HCT1845MB 119,000円 W1800×D450×H10008.9才43.2kg
ASO-HCT1845MW 119,000円 W1800×D450×H10008.9才43.2kg
仕様/天板:抗ウイルスメラミン化粧板 (t22mm) 抗ウイルスABSエッジ(SGRは通常ABS) 天板裏:抗ウイルス バッカ- 脚:スチ-ル 粉体塗装 (B・ブラック、W・ホワイト) 入数:1(4個口)
ASO-S9045B (MAK)
ASO-HCT1845B(NA)
ASO-WC2F-NA(MS)
ASO-CT1845MB(MAK)
ASO-CT1845B(NA)
ASO-CT1845W(WH)
ASO-CT1845MW(BR)
ASO-CTB(LGN)
ASO-CTB(BL)
ASO-HCT1845BMW(NA)
ASO-HCT1845B(BR)
ASO-HCT1845W(MAK)
ASO-HCT1845MB(SGR)
SGR:ストーングレー WH:ホワイト NA:ナチュラル MAK:ミディアムオーク BR:ブラウン
1800mm 398mm 700mm 450mm 1800mm 1000mm 678mm 450mm 046
■SOCIAシリーズ天板カラーサンプル
Cafe table
チェアデスク・収納パーティションテーブルレセプションロビーエクステリアアクセサリー木工







色々なベースにフィットする定番のカフェテーブルで ソロワーク、複数でミーティングなど使い方は多彩です。


ASO-CF750B(SGR)
■SOCIAシリーズ天板カラーサンプル



SGR:ストーングレー WH:ホワイト NA:ナチュラル MAK:ミディアムオーク BR:ブラウン




ASO-CF750W(NA)

ASO-CF750W(BR)
カフェテーブル 価格(税抜) サイズ(mm) 梱包才数梱包重量
ASO-CF750B
ASO-CF750W
64,000円 φ750×H720 3.7才 11kg
64,000円 φ750×H720 3.7才 11kg 仕様/天板:抗ウイルスメラミン化粧板 (t20mm) 抗ウイルスABSエッジ(SGRは通常ABS) 天板裏:抗ウイルスバッカ- 芯材:パ-ティクルボ-ド 脚:スチール 粉体塗装(B・ブラック、W・ホワイト) 入数:1(2個口)




幼保レンタル・リース

カフェテーブル 価格(税抜) サイズ(mm) 梱包才数梱包重量
ASO-CF7575B
ASO-CF7575W
69,000円 W750×D750×H7203.7才 13kg
69,000円 W750×D750×H7203.7才 13kg 仕様/天板:抗ウイルスメラミン化粧板 (t20mm) 抗ウイルスABSエッジ(SGRは通常ABS) 天板裏:抗ウイルスバッカ- 芯材:パ-ティクルボ-ド 脚:スチール 粉体塗装(B・ブラック、W・ホワイト) 入数:1(2個口)
520 720 Φ750 520 720 □750
ASO-CF750B(MAK)
ASO-CF7575B(NA)
ABSエッジ
ABSエッジ
ASO-CF7575B(BR)
ASO-CF7575W(MAK)
ASO-CF7575W(WH)
ASO-CF750B/W
ASO-CF7575B/W
天板は5色から、脚フレームはマットブラックとホワイトからお選びいただけます。
ALES-CTB(BR)
ASO-CF750W(NA)
047 SOCIA
ASO-WC1(IV)
Lounge table

PHN-1200(MAK)

ASO-CF6060W(MAK)





ラウンジソファやベンチで使いやすいサイズです。 棚板付きタイプは、作業スペースを広くします。
■SOCIAシリーズ天板カラーサンプル

BR:ブラウン




SGR:ストーングレー WH:ホワイト NA:ナチュラル MAK:ミディアムオーク

ASO-CF1260B(SGR)
ASO-CF1260W(BR)


ASO-CF1260W(NA)
(t22mm) フラッシュ加工 抗ウイルスABSエッジ(SGRは通常ABS) 天板裏:抗ウイルスバッカ- 脚:スチール 粉体塗装(B・ブラック、W・ホワイト) 入数:1(2個口)

ASO-CF6060B(MAK)

ASO-CF6060B(NA)

ASO-CF6060W(BR)
ASO-CF1260
カフェテーブル 価格(税抜) サイズ(mm)
梱包重量
仕様/天板:抗ウイルスメラミン化粧板 (t22mm) フラッシュ加工 抗ウイルスABSエッジ(SGRは通常ABS) 天板裏:抗ウイルスバッカ- 脚:スチール 粉体塗 装(B・ブラック、W・ホワイト) 入数:1(2個口)


ASO-CF1040B(BR)

ASO-CF1040W(MAK)

ASO-CF6060W(SGR)
ASO-CF6060
カフェテーブル 価格(税抜) サイズ(mm)
仕様/天板:抗ウイルスメラミン化粧板 (t22mm) フラッシュ加工 抗ウイルスABSエッジ(SGRは通常ABS) 天板裏:抗ウイルスバッカ- 脚:スチール 粉体塗 装(B・ブラック、W・ホワイト) 入数:1(3個口)

ASO-CF1040W(WH)
ASO-CF1040
41 5 400 1000 650 15 1 326 328 928 596 528 600 1200 1128 650 596 528 600 600 528 650 カフェテーブル 価格(税抜) サイズ(mm) 梱包才数 梱包重量 ASO-CF1260B 65,000円 W1200×D600×H650 5.4才 24.9kg ASO-CF1260W 65,000円 W1200×D600×H650 5.4才 24.9kg 仕様/天板:抗ウイルスメラミン化粧板
梱包才数
ASO-CF6060B 50,000円 W600×D600×H650 2.9才 17kg ASO-CF6060W 50,000円 W600×D600×H650 2.9才 17kg
ASO-CF1040B 87,000円 W1000×D400×H650 4.0才 25kg ASO-CF1040W 87,000円 W1000×D400×H650 4.0才 25kg
梱包才数 梱包重量
ASO-CF1260W (MAK)
ASO-LS600N(LGN)
ASO-L01W(BR)
048
ASO-CF1040W(NA)
Other Table & Desk ASO-WT











ASO-WT6045B(BR)

ASO-WT6045B(NA)

ASO-WT6045B(WH)


ASO-WT6045B(MAK)
ワークテーブル 価格(税抜) サイズ(mm) 梱包才数 梱包重量 ASO-WT6045B 60,000円 W600×D450×H720 2.2才 15.7kg
仕様/天板:抗ウイルスメラミン化粧板 (t22mm) 抗ウイルスABSエッジ(SGRは通常ABS) 天板裏:抗ウイルスバッカ- 脚:スチ-ル 粉体塗装 (ブラック) 入数:1(2個口)

ASO-ST

ASO-ST400B(NA)
ASO-WT6045B

ASO-ST400B(WH)
(t22mm) 抗ウイルスABSエッジ(SGRは通常ABS) 天板裏:抗ウイルスバッカ- 脚:スチ-ル 粉体 塗装 (ブラック) 入数:1(2個口)

ワークデスク
ASO-WD

ASO-WD6050B(NA)
サイズ(mm)
ASO-ST4540B(SGR)

ASO-ST400B

ASO-WD6050B(SGR)
5.2才 16.1kg 仕様/天板:抗ウイルスメラミン化粧板 (t22mm) 抗ウイルスABSエッジ(SGRは通常ABS) 天板裏:抗ウイルスバッカ- 本体:抗ウイルスメラミン化粧板 脚:スチ-ル 粉体塗装 (ブラック) 入数:1(2個口)

ASO-ST4540B(MAK)
ASO-ST4540B

720 Φ400 Φ440 720 450 400 Φ440 500 720 518 600 698 548 400 450 720 600 サイドテーブル 価格(税抜) サイズ(mm) 梱包才数梱包重量 ASO-ST400B 69,000円 φ440×H720 2.2才15.4kg ASO-ST4540B 71,000円 W450×D440×H7202.2才16.1kg
仕様/天板:抗ウイルスメラミン化粧板
価格(税抜)
梱包才数 梱包重量
ASO-WD6050B
72,000円 W600×D500×H720
内側
WH:ホワイト NA:ナチュラル MAK:ミディアムオーク BR:ブラウン ■SOCIAシリーズ天板カラーサンプル 049 SOCIA チェアデスク・収納パーティションテーブルレセプションロビーエクステリアアクセサリー木工 幼保レンタル・リース
SGR:ストーングレー









テーブルとプランターを結合させた プランターテーブルです。
オフィスグリーンを備え付けることにより 創造性や癒し効果を演出します。








プランターテーブル 価格(税抜) サイズ(mm) 梱包才数梱包重量
ASO-PT1790 214,000円 W1760×D900×H9005.9才 53kg
仕様/天板:パ-ティクルボ-ド 抗ウイルスメラミン化粧板 (t22mm) 抗ウイルスABSエッジ(SGRは通常ABS) 天板裏:抗ウイ ルスバッカ- 本体:パ-ティクルボ-ド 抗ウイルスメラミン化粧板 脚:スチ-ル 粉体塗装 (マットブラック) 入数:1(4個口) ●天板:W1500×D900 ●天板高:H720 ●配線ホ-ル付

プランター片面 ハイテーブル 価格(税抜) サイズ(mm) 梱包才数梱包重量 ASO-PT1271KH 239,000円 W1200×D710×H11005.0才 56kg 仕様/天板:パ-ティクルボ-ド 抗ウイルスメラミン化粧板 (t22mm) 抗ウイルスABSエッジ(SGRは通常ABS) 天板裏:抗ウイ ルスバッカ- 本体:パ-ティクルボ-ド 抗ウイルスメラミン化粧板 脚:スチ-ル 粉体塗装 (マットブラック) 入数:1(4個口) ●天板:W1200×D450 ●天板高:H1000 ●配線ホ-ル付 ●可動棚1枚付

プランター両面 ハイテーブル 価格(税抜) サイズ(mm) 梱包才数梱包重量
ASO-PT1211RH 267,000円 W1200×D1160×H11005.3才 69kg 仕様/天板:パ-ティクルボ-ド 抗ウイルスメラミン化粧板 (t22mm) 抗ウイルスABSエッジ(SGRは通常ABS) 天板裏:抗ウイ ルスバッカ- 本体:パ-ティクルボ-ド 抗ウイルスメラミン化粧板 脚:スチ-ル 粉体塗装 (マットブラック) 入数:1(4個口) ●天板(片側):W1200×D450 ●天板高:H1000 ●配線ホ-ル付 ●可動棚1枚付
260 1160 330 909 450 1160 320 1200 838 1100 1000 プランター内寸: 260 1160 330 909 450 710 320 1200 838 1100 1000 プランター内寸: 1160X220XD5・150・180 プランター内寸: 260 860 200 700 1500 1760 150 900 558 900 720 658 1400
ASO配線ホール
ASO-PT1790(MAK)
ASO-PT1271KH(BR)
ASO-PT1271KH(NA)
ASO-PT1790(WH)
ASO-PT1211RH(NA)
SGR:ストーングレー WH:ホワイト NA:ナチュラル MAK:ミディアムオーク BR:ブラウン ■SOCIAシリーズ天板カラーサンプル
ASO-PT1211RH(BR)
Planter table
プランター内寸:860X220XD5・150・180
ASO-PT1790
プランター内寸:1160X220XD5・150・180
ASO-PT1271KH
プランター内寸:1160X220XD5・150・180
ASO-PT1211RH
050
ASO-PT1271KH(BR) ALES-CTB(BR)
Planter Box
チェアデスク・収納パーティションテーブルレセプションロビーエクステリアアクセサリー木工
ASO-PB






■カラーサンプル

BR:ブラウン

プランターボックス (ハイタイプ) 価格(税抜) サイズ(mm)梱包才数梱包重量
ASO-PB1530H 218,000円 W1500×D300×H11004.5才 ▲ 70kg 仕様/本体:パーティクルボード 抗ウイルスメラミン化粧板(t22mm) 抗ウイルスABSエッジ(SGRは通常ABS) 入数:1





プランターボックス (ロータイプ) 価格(税抜) サイズ(mm)梱包才数梱包重量
ASO-PB1530L 175,000円 W1500×D300×H8003.3才
▲ 54kg
仕様/本体:パーティクルボード 抗ウイルスメラミン化粧板(t22mm) 抗ウイルスABSエッジ(SGRは通常ABS) 入数:1
幼保レンタル・リース
800 1500 300 プランター内寸:W1460×D256×H5/150/180 1100 1500 300 プランター内寸:W1460×D256×H5/150/180
ASO-PB1530H(NA)
ASO-PB1530L(BR)
ASO-PB1530H
ASO-PB1530L
WH:ホワイト SGR:ストーングレー
NA:ナチュラル MAK:ミディアムオーク
CKH22+CKH22-AR+CKH22-HR
ASO-PB1530H(NA)
ASO-BLS(IV)
ASO-T1575(NA)
051 SOCIA
ASO-PB1530L(NA)
Wood chair
ASO-WC1

別張りでシーンに合ったカラーにできる 木製チェア。



座幅を広くとった設計でゆったりとした 座り心地の良い木製チェア

タモ材
やや重みがあり割れや反りが少ない、 ペンキやステインがよく馴染み、つや 出し加工で美しく仕上がる。加工性 も良く釘打ちやネジ、接着の強度が 保たれる。古くから高級家具や工芸 用材として用いられた銘木の一つ。

■カラーサンプル

BL:ブルー

木製チェア 価格(税抜) サイズ(mm) 梱包才数梱包重量
ASO-WC1 41,000円 W470×D560×H765 (SH440)11.9才15.5kg
仕様/張地:布 (ポリエステル) フレ-ム:天然木 (タモ材) ポリウレタン塗装 入数:2(1個口)




木製チェア 価格(税抜) サイズ(mm) 梱包才数梱包重量
ASO-WC1 58,000円 W470×D560×H765 (SH440)11.9才15.5kg
仕様/張地:布 (ポリエステル) フレ-ム:天然木 (タモ材) ポリウレタン塗装 入数:2(1個口)
560 470 420 765 440
ASO-WC1(LGR)
ASO-WC1(IV)
ASO-WC1(BR)
ASO-WC1
ASO-WC1(BL)
背面仕様
ASO-WCA(BL)
ASO-CF750B(NA)
ASO-CF750W(MAK)
LGR:ライトグレー IV:アイボリー BR:ブラウン
052
ASO-WC1(IV)
■カラーサンプル
Wood Chair
チェアデスク・収納パーティションテーブルレセプションロビーエクステリアアクセサリー木工

ASO-WC2T/WC2F-NA
木目の美しさと丈夫なタモ材を使用した リフレッシュチェアです。

タモ材
やや重みがあり割れや反りが少ない、 ペンキやステインがよく馴染み、つや 出し加工で美しく仕上がる。加工性 も良く釘打ちやネジ、接着の強度が 保たれる。古くから高級家具や工芸 用材として用いられた銘木の一つ。



TQ:ターコイズ MS:マスタード GJ:グレージュ ■カラーサンプル


タモ -Ash※製法の特性上、繊維の流れる方向により、色が異なって見えることがあります。

WH:ホワイト
スペイン製 Fabric




木製チェア 価格(税抜) サイズ(mm) 梱包才数梱包重量
ASO-WC2T 38,000円 W445×D475×H765 (SH415)10.4才12kg
仕様/フレ-ム:天然木 (タモ材) ポリウレタン塗装 座:成型合板 突板貼り (タモ材) ポリウレタン塗装 入数:2(1個口)
木製チェア 価格(税抜) サイズ(mm) 梱包才数梱包重量
ASO-WC2F-NA 51,000円 W445×D475×H765 (SH450)10.4才14kg
仕様/フレ-ム:天然木 (タモ材) ウレタン塗装 座:成型合板 突板貼り (タモ材) ポリウレタン塗装 張地:布 (ポリエステル) 入数:2(1個口)

アクアクリーン加工により、 繊維全てが目に見えない分 子被膜で覆われています。


水を加えるだけで汚れが浮 き上がります。 被膜により、汚れが繊維に 浸透するのを防ぎます。

布で拭き取るだけで汚れが 落とせます。

生地にこぼれた汚れをとりのぞきま す。

幼保レンタル・リース

汚れを直接、または水で湿らせた 吸水性の高い布で濡らし、数秒待 ちます。
汚れに布を押し当て、円を描くよう に生地を優しくこすります。
475 440(背) 390 765 450 445(座) 475 440(背) 390 765 415 445(座)
ASO-WC2F-NA
ASO-WC2T
ASO-WC2T(NA) 背面仕様
ASO-WC2F-NA(GJ)
ASO-WC2F-NA(MS)
ASO-WC2F-NA(TQ)
ASO-WC2F-NA(WH)
ASO-WC2F-NA(MS)
053 SOCIA
ASO-WC2F-NA(GJ)
オフィスチェア
豊富な機能、大きめな背座による着座時のリラックス感 ワークベースでの効率アップにおすすめです。

背をしっかりサポート、快適な座り心地のメッシュチェア。
CKH11



オフィスチェア メッシュ張り
価格(税抜) サイズ(mm) 梱包才数梱包重量
CKH11 44,000円 W490×D580×H1005~1055 (SH435~485) 6.8才14kg 仕様/張地:背・座/メッシュ (ポリエステル) 脚:エンプラ樹脂成型品 (ブラック) 入数:1 ●座昇降 (ガスシリンダ-式) 機能付 ●シンクロロッキング機構付 ●背固定機能付 ●ランバ-サポ-ト (左右セパレ-ト式)


肘可動 オプション肘は体格に合わせて高さ を調整できます。

BL:ブルー BK:ブラック ■カラーサンプル


背・座メッシュ 背・座のポリエステルメッシュ素材 が快適な座り心地と、長時間着 座時のムレを防ぎます。

ランバーサポート 標準装備のランバーサポートは、 体格に合わせて左右を自由に調整 でき、しっかりと身体を支えることが 可能です。

シンクロロッキング ロッキング時に身体の動きに合わ せ、背・座が連動して動き、適正 な着座姿勢を維持します。

背固定機能 多段階に背もたれの角度を固定で きます。
オプション肘 (左右セット) 価格(税抜) サイズ(mm) 梱包才数梱包重量
CKH11-AR 7,800円 W84×D240×H269 3.4才8.5kg
仕様/本体:ナイロン樹脂成型品 (ブラック) パット:ポリウレタン樹脂成型品 (ブラック) 入数:5(1個口) ●肘高さ調節機能付
640 (肘) 648 580 435 ~ 485 1005 ~ 1055 490 (座) 455 600 ~ 731 490 (座) 648 580 435 ~ 485 1005 ~ 1055 480 (背) 455
CKH11
CKH11(BK)
CKH11(BL)
CKH11(BL)+CKH-AR
CKH11-AR
CKH11+CKH11-AR
11段階で10mmピッチ
ASO-S9045B(MAK)
CKH11(BK)+CKH11-AR
054
ASO-W1811B(NA)
チェア
チェアデスク・収納パーティションテーブルレセプションロビーエクステリアアクセサリー木工
背座一体型のコンパクトなチェアです。 ワークやミーティングなどあらゆるシーンに

■カラーサンプル






幼保レンタル・リース
チェア 価格(税抜)
サイズ(mm) 梱包才数梱包重量
ASO-OC1 24,000円 W460×D500×H770~845 (SH415~490)3.9才8kg
仕様/張地:布 (ポリエステル) 脚:スチ-ル 粉体塗装 (ブラック) 入数:1 ●座昇降 (ガスシリンダ-式) 機能付
500 460 365 526 770 ~ 845 41 5 ~ 490
ASO-OC1
ASO-OC1(BL)
ASO-OC1(GN)
ASO-OC1(GR)
GR:グレー
GN:グリーン BL:ブルー
G-AP15
ASO-CF1260W(NA)
ASO-OC1(GR)
055 SOCIA
QSB-1510(BL-BL) P149
テーブル CFL-T80B(WT) P.235

ALES
■カラーサンプル 合板




NA:ナチュラル AK:オーク

CH:チェリー
BR:ブラウン


(パットなしのみ)

ALES-NA-B 合板:ブラウン 脚 :黒塗装 合板:チェリー 脚 :黒塗装 合板:オーク 脚 :黒塗装 合板:ナチュラル 脚 :黒塗装
チェアパッドなし黒塗装脚 価格(税抜)
サイズ(mm) 梱包才数梱包重量
ALES-□-B 25,700円 W505×D505×H855 (SH440)12.8才17kg 仕様/背・座:成型合板 メラミン化粧貼り フレ-ム:スチ-ル (φ15.9mm) 入数:4 ●スタッキング可能 (4脚まで)
※発注方法は P112 を参照ください。
■カラーサンプル 張地(布)

合 板:ブラウン 脚 :黒塗装 パッド:ブラック(布)

FBK:ブラック

チェアパッド付黒塗装脚 価格(税抜)

FBL:ブルー

FBR:ブラウン

合 板:チェリー 脚 :黒塗装 パッド:ブルー(布)

FGN:グリーン

FMS:マスタード

合 板:ナチュラル 脚 :黒塗装 パッド:グリーン(布)
サイズ(mm) 梱包才数梱包重量
ALES-P-□-□-B 33,900円 W505×D505×H855 (SH460)13.3才19kg 仕様/背・座:成型合板 メラミン化粧貼り フレ-ム:スチ-ル (φ15.9mm) 張地:布 入数:4 ●スタッキング不可
※発注方法は P112 を参照ください。

FPK:ピンク


合 板:オーク 脚 :黒塗装 パッド:ピンク(布)
420 (座) 430 505 505 460 855 420 (座) 430 505 505 440 855 595 1000 スタッキング/ 4脚
ALES-P-CH-BR-B
ALES-P-CH-IV-B
ALES-BR-B
ALES-P-BR-FBK-B
ALES-P-CH-FBL-B
ALES-P-MP-FMS-B
ALES-P-NA-FGN-B
ALES-CH-B
ALES-MP-B
ALES
056


Counter Chair
ASO-CTB








BR:ブラウン BL:ブルー


LGN:ライトグリーン
■カラーサンプル ※製法の特性上、繊維の流れる方向により、色が異なって見えることがあります。


PK:ピンク
カウンターチェア 価格(税抜)サイズ(mm)梱包才数梱包重量
ASO-CTB 41,000円 W505×D520×H7756.1才12.7kg
仕様/張地:布 フレ-ム:スチ-ル (φ15.9mm) 粉体塗装 (ブラック) 入数:2 ●スタッキング不可
■カラーサンプル




GR:グレー GN:グリーン BK:ブラック BR:ブラウン


WN:ワイン NA:ナチュラル

フットレスト

フットレストは、錆びにくいステンレスとすべり にくいPVCを採用しています。
幼保レンタル・リース
ハイチェア 価格(税抜)サイズ(mm)梱包才数梱包重量
ASO-HC320C 38,000円 W400×D345×H7154.8才11.5kg
ASO-HC320W 24,000円 W400×D345×H6904.5才12kg
仕様/座:(C)合成皮革・(W)天然木 フレ-ム:スチ-ル (φ15.9mm) 入数:2
●スタッキング不可
380 520 280 775 400 505 345 280 715 320 400 345 280 690 320 400
ASO-HC320
ASO-CTB(BL)
ASO-CTB(BR)
ASO-CTB(LGN)
ASO-CTB(PK)
ASO-CTB(LGN)
ASO-CTB(BL)
ASO-HC320W(NA)
ASO-HC320C(BK) ASO-HC320C(GR) ASO-HC320C(WN)
ASO-HC320C ASO-HC320W
ASO-HCT1845B(NA)
ASO-HC320C(GN)
057 SOCIA
ASO-HC320C(WN)
チェアデスク・収納パーティションテーブルレセプションロビーエクステリアアクセサリー木工
Antiviral Screen 抗ウイルス・抗菌機能付きクロススクリーンです。 増結可能で多彩なアレンジが可能です。

ASO-SP
3連パネル

単体パネル

抗菌・抗ウイルス
●約20種類の微生物(細菌・真菌・ウイルス)に対する効果を確認し ています。
●例えば、生乾きの嫌なニオイの原因になる細菌にも。
●効果はすべて繊維上の微生物に対するものです。


間仕切りとしてだけでなく、ラウンジソファとの組み合わせで 集中ワークエリアやプライベート感のあるエリアが設置可能です。



抗ウィルススクリーン3連 価格(税抜) サイズ(mm)梱包才数梱包重量
ASO-SP3B 135,000円 W700×D20×H1500×3枚1.9才12kg
ASO-SP3W 135,000円 W700×D20×H1500×3枚1.9才12kg 仕様/パネル:布 パネル枠:スチ-ル 粉体塗装 入数:1 ●連結可能 ●アジャスタ-付




抗ウイルススクリーン増設 価格(税抜) サイズ(mm)梱包才数梱包重量
ASO-SP1B 46,000円 W700×D20×H15000.6才4kg
ASO-SP1W 46,000円 W700×D20×H15000.6才4kg
仕様/パネル:布 パネル枠:スチ-ル 粉体塗装 入数:1 ●連結可能 ●アジャスタ-付
抗菌・抗ウイルス機能繊維加工技術「CLEANSE®/クレンゼ®」は、固定化抗菌成分「Etak®/イータック」を 活用し、繊維表面に強力に固定化するクラボウ独自の加工技術です。
675 (内寸) 1400 700 (外寸) 700 (内寸) 750 (外寸) 675 (内寸) 700 (外寸) 700 23 655 350 750 1500 400 85 700 655 350 750 1500 400 85
ASO-SP3B/ SP3W
23
ASO-SP1B/ SP1W
ASO-SP3B(GR)
ASO-SP3B(NV)
ASO-SP3W(GR)
ASO-SP3W(NV)
ASO-SP1B(NV) ASO-SP1B(GR)
ASO-SP1W(NV) ASO-SP1W(GR)
ASO-SP1W/SP1B
NV:ネイビー GR:グレー ■カラーサンプル
ASO-CF1260B(NA)
ASO-ST400B(MAK)
058
ASO-OC1(GR)
1
チェアデスク・収納パーティションテーブルレセプションロビーエクステリアアクセサリー木工

3
2
4 ¥273,000円 ¥502,000円 ¥231,000円 ¥805,000円



幼保レンタル・リース
座ると周囲から視線が遮られ、立った状態は周囲を見渡せる高さ。 使用上の注意点
・2枚以上連結してご使用ください。単体の自立機能はありません。 ・2枚以上連結時はL型、3枚連結時はL型もしくはコ型、4枚以上の連結 時は直線は3枚までとし、1枚はL型になるようにレイアウトしてください。 軽量スクリーンに寄り掛かったり、ものを立てかけたりしないでください。 転倒する恐れがあります。
品番 数量 価格(税抜) ASO-SP1W(GR) ×1 46,000円 ASO-SP1W(NV) ×1 46,000円 ASO-LS600S(PK) ×1 110,000円 ASO-ST4540B(SGR) ×1 71,000円 合計 273,000円 品番 数量 価格(税抜) ASO-SP3W(GR) ×1 135,000円 ASO-WD6050B(MAK) ×1 72,000円 ASO-OC1(GR) ×1 24,000円 合計 231,000円 品番 数量 価格(税抜) ASO-SP3B(GR) ×1 135,000円 ASO-SP1B(NV) ×2 46,000円 ASO-WD6050B(MAK) ×1 72,000円 ASO-ST400B(MAK) ×1 69,000円 ASO-OC1(GR) ×1 24,000円 ASO-LS600S(BJ) ×1 110,000円 合計 502,000円 品番 数量 価格(税抜) ASO-SP3B(GR) ×1 135,000円 ASO-SP3B(NV) ×1 135,000円 ASO-SP1B(NV) ×1 46,000円 ASO-DT1290B(MAK) ×1 165,000円 RO-S1200(FBJ) ×2 162,000円 合計 805,000円 23 700 1500 85 セット プラン
セット プラン
セット プラン
セット プラン
059 SOCIA
Box Sofa & Center Table

 ASO-BLS(LGR)
CK03(GN)
ASO-BLS(IV)
ASO-ST400R(SGR)
ASO-PB1530H(NA)
ASO-PB1530L(NA)
ASO-OT1260(MAK)
ASO-BLS(LGR)
CK03(GN)
ASO-BLS(IV)
ASO-ST400R(SGR)
ASO-PB1530H(NA)
ASO-PB1530L(NA)
ASO-OT1260(MAK)
060
ASO-BLS
チェアデスク・収納パーティションテーブルレセプションロビーエクステリアアクセサリー木工
ASO-BLS(BR)
オフィス、カフェ、ラウンジなど様々なシーンで使用できる収納ボックスソファ。 使用環境に応じた備品等を保管できます。


ASO-BLS(LGR)


収納付き
片側内寸:W700×D490×H189 ㎜ 使用環境に応じた備品や生活必需品の保管、 防災関連グッズ等の収納に重宝します。

収納ボックスソファ 価格(税抜) サイズ(mm) 梱包才数梱包重量
ASO-BLS 260,000円 W1500×D600×H730(SH400)26才 48kg
仕様/背・座:チップウレタン布張り(アクリル40%、ポリエステル30%、綿30%) 台輪:抗ウイルスメラミン化粧板 入数:1(3個口) ●収納機能付 ●収納内寸:W700×D490×H189㎜×2 ●ダブルステッチ仕様 ●アジャスター付
抗ウイルス センターテーブル
ASO-OT


抗ウイルスセンター テーブル 価格(税抜) サイズ(mm)
■カラーサンプル

BR:ブラウン

LGR:ライトグレー
ダブルステッチ縫製 デザインのアクセントとして、 ブラック色のダブルステッチ で縫製しています。

IV:アイボリー
■台輪カラーサンプル

SGR:ストーングレー
ASO-BLS
■カラーサンプル







幼保レンタル・リース
梱包才数梱包重量
420 1200 1118 380 600 730 1500 400 250 150 1480 700 490 189 540 600 400 315
W1200×D600×H4202.8才
仕様/天板:抗ウイルスメラミン化粧板(30㎜厚) 共張り 天板裏:抗ウイルスバッカー 側板:抗ウイルスメラミン化粧板 入数:1
ASO-OT1260 130,000円
22kg
●アジャスター付
ASO-OT1260
SGR:ストーングレー WH:ホワイト NA:ナチュラル MAK:ミディアムオーク BR:ブラウン
ASO-OT1260(MAK)
ASO-OT1260(BR)
ASO-OT1260(WH)
ASO-OT1260(NA)
061 SOCIA
Lounge Sofa
キューブタイプのソファ
ソフトなカラーと天然木がオフィスに憩いのスペースを演出します。

ASO-LS600


Lounge Sidetable



LGN:ライトグリーン BL:ブルー BJ:ベージュ ■カラーサンプル



PK:ピンク
※製法の特性上、繊維の流れる方向により、色が異なって見えることがあります。

タモ -Ashウェービングベルトクッション

タモ材 やや重みがあり割れや反りが少ない、 ペンキやステインがよく馴染み、つや 出し加工で美しく仕上がる。加工性 も良く釘打ちやネジ、接着の強度が 保たれる。古くから高級家具や工芸 用材として用いられた銘木の一つ。
ウェービングベルトの伸縮により、クッション性が 向上し柔らかな座り心地が得られます。


ラウンジソファ 価格(税抜)サイズ(mm)梱包才数梱包重量
ASO-LS600N 94,000円 W600×D600×H4355.3才14.8kg
仕様/張地:布 (ポリエステル) 座:木枠 フレ-ム:天然木 (タモ材) ポリウレタン塗装 入数:1(2個口)



ラウンジソファ 価格(税抜)サイズ(mm)梱包才数梱包重量
ASO-LS600S 110,000円 W600×D600×H750 (SH435) 10.1才16.9kg
仕様/張地:布 (ポリエステル) 座:木枠 フレ-ム:天然木 (タモ材) ポリウレタン塗装 入数:1(2個口)




SGR:ストーングレー WH:ホワイト NA:ナチュラル MAK:ミディアムオーク BR:ブラウン ■カラーサンプル


ラウンジサイドテーブル 価格(税抜)
サイズ(mm)梱包才数梱包重量
ASO-LT8050 120,800円 W800×D500×H4301.3才19.6kg 仕様/天板:抗ウイルスメラミン化粧板 (t22mm) 天板裏:抗ウイルスパッカ- 本体:抗ウイルスメラミン化粧板
□600 435 15 1 755 600 450 600 435 15 1 234 500 430 756 800 234 288 258 1 28 494 450
入数:1
ASO-LT8050(NA)
ASO-LT8050(BR)
ASO-LS600N(BJ)
ASO-LS600S(BL)
ASO-LS600S(BJ)
ASO-LS600S(PK)
ASO-LS600S(LGN)
ASO-LS600N(BL)
ASO-LS600N(LGN)
ASO-LS600N(PK)
ASO-LS600N
ASO-LS600S
ASO-LT8050
062
ASO-WT6045B(SGR)
Lounge Bench ちょっと休息に最適なコンパクトベンチです。
レイアウトも多彩、色合わせも多彩で雰囲気の変化が楽しめます。
チェアデスク・収納パーティションテーブルレセプションロビーエクステリアアクセサリー木工

ASO-L




■カラーサンプル




PK:ビンク
LGN:ライトブリーン
※製法の特性上、繊維の流れる方向により、色が異なって見えることがあります。
■天板カラーサンプル

NA:ナチュラル

ラウンジベンチ 価格(税抜) サイズ(mm)梱包才数梱包重量
ASO-L01B 61,000円 W500×D500×H4301.8才8.5kg
ASO-L01W 61,000円 W500×D500×H4301.8才8.5kg
仕様/座:合板 スラブウレタン+チップウレタン 布張り (ポリエステル100%) 脚:スチ-ル (〼31mm) スチール 粉体塗装(B・ブラック、W・ホワイト) 入数:1

ラウンジベンチ 価格(税抜)

サイズ(mm)梱包才数梱包重量
ASO-L02B 89,000円 W1000×D500×H4303.5才14kg
ASO-L02W 89,000円 W1000×D500×H4303.5才14kg
仕様/座:合板 スラブウレタン+チップウレタン 布張り (ポリエステル100%) 脚:スチ-ル (〼31mm) スチール 粉体塗装(B・ブラック、W・ホワイト) 入数:1

ラウンジベンチ(天板付) 価格(税抜)

サイズ(mm)梱包才数梱包重量
ASO-L02TB 89,000円 W1000×D500×H4303.5才15kg
ASO-L02TW 89,000円 W1000×D500×H4303.5才15kg
仕様/座:合板 スラブウレタン+チップウレタン 布張り (ポリエステル100%) 天板:抗ウイルスメラミン 抗ウイルスABSエッジ 天板 裏:抗ウイルスバッカ- 脚:スチ-ル(〼31mm) スチール 粉体塗装(B・ブラック、W・ホワイト) 入数:1 ●天板高:352mm






ラウンジベンチ 価格(税抜) サイズ(mm)梱包才数梱包重量
ASO-L03B 120,000円 W1500×D500×H4305.3才18kg
ASO-L03W 120,000円 W1500×D500×H4305.3才18kg
仕様/座:合板 スラブウレタン+チップウレタン 布張り (ポリエステル100%) 脚:スチ-ル (〼31mm) スチール
粉体塗装(B・ブラック、W・ホワイト) 入数:1
ASO-LO2B・ASO-LO2W





ASO-LO2TB・ASO-LO2TW
幼保レンタル・リース

ASO-LO3B・ASO-LO3W
430 418 500 290 398 500 430 918 500 290 500 1000 398 500 352 918 398 500 500 290 500 1000 430 430 1418 398 500 500 290 500 1500 500
ASO-L02W(BL)
ASO-L02W(PK)
ASO-L02B(LGN) ASO-L02B(BR)
ASO-L02TB(BL)
ASO-L02TB(LGN) ASO-L02TW(PK)
ASO-L02TW(BR)
ASO-L03W(BR) ASO-L03B(PK)
ASO-L03W(LGN)
ASO-L03B(BL)
ASO-LO1B・ASO-LO1W
ASO-L01B(BR) ASO-L01B(PK)
ASO-L01W(BL)
ASO-L01W(LGN)
BR:ブラウン BL:ブルー
PHN-1200(MAK)
ASO-L02B(BR)
ASO-L02TB(BR)
ASO-CF1260B(BR)
063 SOCIA
ASO-L01B(LGN)



ASO-SB







システムベンチ 価格(税抜) サイズ(mm)梱包才数梱包重量
ASO-SB1200R 132,000円 W1200×D565×H3803.2才25kg 仕様/天板:パーティクルボード 抗ウイルスメラミン化粧板(t30mm)ABSエッジ 抗ウイルスABSエッジ(SGRは 通常ABS) 本体:メラミン化粧板 入数:1





システムベンチ 価格(税抜) サイズ(mm)梱包才数梱包重量
ASO-SB900S 99,000円 W900×D450×H3801.9才22kg 仕様/天板:パーティクルボード 抗ウイルスメラミン化粧板(t30mm)ABSエッジ 抗ウイルスABSエッジ(SGRは 通常ABS) 本体:メラミン化粧板 入数:1
450 900 840 380 380 350 227127 850 850 450 1200
380 350
R850
ASO-SB900S(MAK)
System
ASO-SB900S ASO-SB1200R
ASO-SB1200R(BR)
Bench
SGR:ストーングレー
WH:ホワイト NA:ナチュラル MAK:ミディアムオーク
BR:ブラウン
■カラーサンプル
ASO-ST400R(SGR)
ASO-SB1200R(MAK)
ASO-SB1200R(MAK)
ASO-SB900S(MAK)
ASO-PB1530H(NA)
ASO-ST400R(NA)
CK03(GN)
ASO-W1111W(WH)
064
ASO-SB1200R(MAK)

Shalf
チェアデスク・収納パーティションテーブルレセプションロビーエクステリアアクセサリー木工


ASO-S 奥行600mmタイプ




カラーバリエーションが豊富なオープンシェルフ。 ディスプレイ棚から空間を間仕切るなど 様々なレイアウトに対応します。


G-TN18
■SOCIAシリーズ天板カラーサンプル








仕様/天板:抗ウイルスメラミン化粧板 (t20mm) 抗ウイルスABSエッジ(SGRは通常ABS) 天板裏:抗ウイルスバッカ- 棚板:抗ウイルスメラミン 化粧板 (t17mm) 脚:スチール 粉体塗装(B・ブラック、W・ホワイト) 入数:1(3個口)
奥行450mmタイプ



幼保レンタル・リース

(t20mm) 抗ウイルスABSエッジ(SGRは通常ABS) 天板裏:抗ウイルスバッカ- 棚板:抗ウイルスメラミン 化粧板 (t17mm) 脚:スチール 粉体塗装(B・ブラック、W・ホワイト) 入数:1(3個口)
37 404 450 900 854 331331331 1130 37 554 600 900 854 331331331 1130 シェルフ 価格(税抜) サイズ(mm) 梱包才数梱包重量 ASO-S9060B 126,000円 W900×D600×H1130 5.7才 47.2kg ASO-S9060W 126,000円 W900×D600×H1130 5.7才 47.2kg
シェルフ 価格(税抜) サイズ(mm) 梱包才数梱包重量 ASO-S9045B 101,000円 W900×D450×H1130 4.0才 40.5kg ASO-S9045W 101,000円 W900×D450×H1130 4.0才 40.5kg 仕様/天板:抗ウイルスメラミン化粧板
ASO-S9060B(BR)
ASO-S9045W(BR)
ASO-S9060B(MAK)
ASO-S9045W(MAK)
ASO-S9060W(SGR)
ASO-S9045B(NA)
ASO-S9060W(WH)
ASO-S9045B(SGR)
ASO-S9045B(BR)
ALES-CTB(NA) ASO-S9060B(NA)
ASO-HCT1845B(NA)
ASO-S9045
SGR:ストーングレー WH:ホワイト NA:ナチュラル MAK:ミディアムオーク BR:ブラウン
065 SOCIA
ASO-S9060
Personal Locker SOCIAの各ベースにフィットする個人用ロッカーです。 鍵とポストを備え、テレワーク社員の書類も管理が容易です。


■扉カラーサンプル


BK:ブラック ■本体カラーサンプル











木製パーソナルロッカー 価格(税抜) サイズ(mm) 梱包才数梱包重量
仕様/天板:ポリエステル化粧板 フラッシュ加工 本体:パ-ティクルボ-ド プリント紙化粧板貼り 扉:パ-ティクルボ-ド プリント紙化粧板貼り 入数:1(2個口) ●鍵付 (各2個) ●ネ-ムプレ-ト付 ●可動棚4枚付 ●アジャスタ-付 ●背面化粧板貼り
11 10 900 416 119382 400
PRO-4W
円 W900×D400×H1110 5.3才 41kg PRO-4B 92,000円 W900×D400×H1110 5.3才 41kg
92,000
収納例2
PRO-4B(NA)(ネームプレート付)
収納例1
PRO-4W(NA)(ネームプレート付)
収納例3
鍵付
ポスト投函口
天板活用法
PRO-4
可動棚付き(30㎜ピッチ)
ポスト内部
PRO-4
PRO-4W
NA:ナチュラル
WH:ホワイト
066
PRO-4B
チェアデスク・収納パーティションテーブルレセプションロビーエクステリアアクセサリー木工

LOCKER
















PMR-3B 128,000円 W900×D500×H10606才 48kg 仕様/天板:抗ウイルスメラミン化粧板(22㎜厚) 抗ウイルスABSエッジ 天板裏:抗ウイルスバッカー 本体・扉:プリント紙化粧板貼り 脚:スチール粉体塗装 入数:1(4個口) ●鍵付(各2個) ●ネームプレート付 ●アジャスター付 ●背面化粧板貼り ●ハンガーパイプ付
1060 900 269 105 840 500 773 460 450
木製パーソナル ロッカー 価格(税抜) サイズ(mm) 梱包才数梱包重量
PMR-3B PMR-3B
ポスト投函口
ネームプレート
天板活用例
PMR-3B
ポスト内部
鍵付き
ハンガーパイプ
PHN-1200(MAK)
PMR-3B(MAK)
KOL-F1(BR)
使用例1
使用例2
MAK:ミディアムオーク BK:ブラック 本体
天板
067 SOCIA
■カラーサンプル
幼保レンタル・リース
Planter Hanger

Office Green


G-IB
アイビー 10,500円(税抜) サイズ:W220×D220×H230mm 花器サイズ:上面/Φ100、底面/Φ60、高さ/80mm 葉 :ポリエステル+ポリエチレン 花 器:ポリプロピレン 入 数:1 梱包才数:0.2才 梱包重量:0.4kg ●光触媒


G-HIB
斑入りアイビー 10,500円(税抜) サイズ:W220×D220×H230mm 花器サイズ:上面/Φ100、底面/Φ60、高さ/80mm 葉 :ポリエステル+ポリエチレン 花 器:ポリプロピレン 入 数:1 梱包才数:0.2才 梱包重量:0.4kg ●光触媒
ラックは左右移動します。


MAK:ミディアムオーク
プランターハンガー 価格(税抜) サイズ(mm)梱包才数梱包重量 PHN-1200(MAK) 98,000円 W1200×D515×H16003.8才20kg 仕様/コ-トハンガ-本体:スチ-ル 楕円パイプ (40×20mm) 粉体塗装 (マットブラック) ハンガ-パイプ:スチ -ル (φ25.4mm) クロ-ムメッキ キャスタ-:φ40mm双輪キャスタ- プランタ-本体:抗ウイルスメラミン化粧 板 抗ウイルスパッカ- 入数:1(2個口) ●器差込口:φ90 ●器差込口:6個付

G-SMG
ミックスグリーンS
13,200円(税抜)
サイズ:W310×D250×H280mm
花器サイズ:上面/Φ100、底面/Φ60、高さ/80mm
葉 :ポリエステル+ポリエチレン 花 器:ポリプロピレン 入 数:1 梱包才数:0.6才 梱包重量:0.7kg ●光触媒

G-MLL
ミニリーフL
16,500円(税抜)
サイズ:W250×D250×H360mm 花器サイズ:上面/Φ100、底面/Φ60、高さ/80mm 葉 :ポリエステル+ポリエチレン 花 器:ポリプロピレン 入 数:1 梱包才数:0.6才 梱包重量:0.8kg ●光触媒

G-MLGW
ミニリーフG/W 10,500円(税抜) サイズ:W200×D200×H210mm 花器サイズ:上面/Φ100、底面/Φ60、高さ/80mm 葉 :ポリエステル+ポリエチレン 花 器:ポリプロピレン 入 数:1 梱包才数:0.2才 梱包重量:0.3kg ●光触媒
120 528 1454 Φ90 533 277 480 572 350 1200 1160 1356 116 1600 515
使用例1
使用例2
■カラーサンプル ※特性上予告なく廃番になる事があります。
PHN-1200(MAK)
G-SMG
G-IB
G-HIB
G-MLL
068
G-MLGW

CoMbⅠ。









Φ350 Φ220
400 380
抗菌 サークルボックス 価格(税抜) サイズ(mm)梱包才数梱包重量 CoMbI。 15,000円 φ350×H400mm8.3才8.5kg
仕様/本体:ポリプロピレン樹脂成型品+ポリエチレン樹脂成型品 入数:6
※10号サイズ(鉢直径30cmの鉢に対応しています。)

幼保レンタル・リース
CoMbI。+G-TN18
抗菌サークルボックス+トリネコ1.8 115,000円(税抜) サイズ:W750×D750×H1800mm 花器サイズ:上面/Φ305、底面/Φ210、高さ/305mm 葉 :ポリエステル+ポリエチレン+天然木 花 器:ポリプロピレン 入 数:1 梱包才数:9.7才 梱包重量:8.6kg ●光触媒

CombI。+G-OVT16
抗菌サークルボックス+オリーブツリー1.6 100,800円(税抜)
サイズ:W550×D550×H1600mm 花器サイズ:上面/Φ305、底面/Φ210、高さ/305mm 葉 :ポリエステル+ポリエチレン+天然木 花 器:ポリプロピレン 入 数:1 梱包才数:8.8才 梱包重量:8.3kg
●光触媒
CoMbI。(DGR)+G-TN18 CoMbI。(LBJ)+G-OVT16
CoMbI。(LGR)+G-OVT16
CoMbI。(LBJ)+G-TN18
Combi
CoMbI。(DGR) CoMbI。(LBJ) CoMbI。(LGR)
LGR:ライトグレー LBJ:ライトベージュ
DGR:ダークグレー ■カラーサンプル
CoMbⅠ。(LGR)+G-TN18
069 SOCIA チェアデスク・収納パーティションテーブルレセプションロビーエクステリアアクセサリー木工
CoMbⅠ。(DGR)+G-OVT16
Office Green


G-YK16
ユッカ1.6 73,700円(税抜)
サイズ:W650×D600×H1600mm 花器サイズ:上面/Φ305、底面/Φ210、高さ/305mm 葉 :ポリエステル+ポリエチレン+ウレタン 花 器:ポリプロピレン
入 数:1 梱包才数:8.8才 梱包重量:8kg ●光触媒
光触媒人工植物は本物のような美しさでオフィスの 空気までクリーンにしてくれます。

G-KB135
カシワバゴム1.35 63,800円(税抜)
サイズ:W550×D550×H1350mm 花器サイズ:上面/Φ226、底面/Φ140、高さ/246mm 葉 :ポリエステル+ポリエチレン 幹 :天然木 花 器:ポリプロピレン 入 数:1 梱包才数:5.1才 梱包重量:5.4kg ●光触媒

G-AP15
アレカパーム1.5
85,000円(税抜) サイズ:W750×D750×H1500mm 花器サイズ:上面/Φ305、底面/Φ210、高さ/305mm 葉 :ポリエステル+ポリエチレン 花 器:ポリプロピレン 入 数:1 梱包才数:8.8才 梱包重量:6.9kg ●光触媒

G-STL16
ストレチア1.6 75,900円(税抜) サイズ:W650×D600×H1600mm 花器サイズ:上面/Φ325、底面/Φ228、高さ/385mm 葉 :ポリエステル+ポリエチレン 花 器:ポリプロピレン 入 数:1 梱包才数:8.8才 梱包重量:8.5kg ●光触媒

G-OVT16
オリーブツリー1.6 85,800円(税抜)

サイズ:W550×D550×H1600mm 花器サイズ:上面/Φ305、底面/Φ210、高さ/305mm 葉 :ポリエステル+ポリエチレン+天然木 花 器:ポリプロピレン 入 数:1 梱包才数:8.8才 梱包重量:8.3kg ●光触媒


G-TN18
トリネコ1.8 100,000円(税抜)
サイズ:W750×D750×H1800mm 花器サイズ:上面/Φ305、底面/Φ210、高さ/305mm 葉 :ポリエステル+ポリエチレン+天然木 花 器:ポリプロピレン 入 数:1 梱包才数:9.7才 梱包重量:8.6kg ●光触媒
G-MS18
モンステラ1.8 127,000円(税抜)
サイズ:W600×D600×H1800mm 花器サイズ:上面/Φ365、底面/Φ250、高さ/365mm 葉 :ポリエステル+ポリエチレン 幹 :天然木 花 器:ポリプロピレン 入 数:1 梱包才数:▲ 14.3才 梱包重量:12kg ●光触媒
G-KB135
G-STL16
G-YK16
G-OVT16
G-TN18
G-MS18
※特性上予告なく廃番になる事があります。 070
G-AP15
Office Green
チェアデスク・収納パーティションテーブルレセプションロビーエクステリアアクセサリー木工

G-MSG
ミックスグリーンS
11,200円(税抜)
サイズ:W310×D250×H280mm 花器サイズ:上面/Φ116、底面/Φ70、高さ/120mm 葉 :ポリエステル+ポリエチレン 花 器:ポリプロピレン
入 数:1 梱包才数:0.6才 梱包重量:0.7kg ●光触媒

G-PLP
ポールライムポトス
34,500円(税抜)
サイズ:W360×D360×H820mm 花器サイズ:上面/Φ245、底面/Φ170、高さ/245mm 葉 :ポリエステル+ポリエチレン 花 器:ポリプロピレン 入 数:1 梱包才数:3.9才 梱包重量:3.8kg ●光触媒

G-PK90
パキラ90
36,300円(税抜)
サイズ:W480×D480×H900mm 花器サイズ:上面/Φ184、底面/Φ120、高さ/199mm 葉 :ポリエステル+ポリエチレン 幹 :天然木 花 器:ポリプロピレン 入 数:1 梱包才数:3.9才 梱包重量:4.2kg ●光触媒
フロアタイプから壁掛けタイプまで自然を感じる 温もり溢れる空間を造ることができます。

G-2TH
ツートンホヤ
21,400円(税抜)
サイズ:W400×D400×H400mm 花器サイズ:上面/Φ145、底面/Φ90、高さ/150mm 葉 :ポリエステル+ポリエチレン 花 器:ポリプロピレン 入 数:1 梱包才数:1.2才 梱包重量:1.2kg ●光触媒

G-TH
ティグラスハンガー (ポリ製)
13,400円(税抜)
サイズ:W200×D200×H750mm 花器サイズ:上面/Φ100、底面/Φ60、高さ/80mm 葉 :ポリエチレン 花 器:ポリプロピレン 入 数:1 梱包才数:1.2才 梱包重量:0.7kg ●光触媒

G-GL
ゴールデンリーフ
41,800円(税抜)
サイズ:W500×D450×H1200mm 花器サイズ:上面/Φ214、底面/Φ120、高さ/299mm 葉 :ポリエステル+ポリエチレン 幹 :天然木 鉢 :ポリプロピレン バ-グ:廃ガラス 入 数:1 梱包才数:5.1才 梱包重量:4.5kg ●鉢サイズ:φ215×H230mm

G-FR
壁掛けフィロ 19,800円(税抜)
サイズ:W230×D180×H680mm 花器サイズ:上面/〼80、底面/〼65、高さ/75mm 葉 :ポリエステル+ポリエチレン 花 器:天然葉 (ヒヤシンス) 入 数:1 梱包才数:0.6才 梱包重量:0.7kg ●光触媒

G-B
ベンジャミン
41,800円(税抜)

G-KSP
壁掛けシュガーバイン
20,900円(税抜)
サイズ:W150×D150×H720mm 花器サイズ:上面/〼80、底面/〼65、高さ/75mm 葉 :ポリエステル+ポリエチレン 花 器:天然葉 (ヒヤシンス) 入 数:1 梱包才数:0.6才 梱包重量:0.4kg ●光触媒

幼保レンタル・リース
G-GH
ウォーターグラスハンガー (ポリ製) 24,200円(税抜)
サイズ:W500×D450×H1250mm 花器サイズ:上面/Φ214、底面/Φ120、高さ/299mm 葉 :ポリエステル+ポリエチレン 幹 :天然木 鉢 :ポリプロピレン バ-グ:廃ガラス 入 数:1 梱包才数:5.1才 梱包重量:5.6kg ●鉢サイズ:φ215×H230mm
サイズ:W200×D200×H900mm 花器サイズ:上面/Φ100、底面/Φ60、高さ/80mm 葉 :ポリエチレン 花 器:ポリプロピレン 入 数:1 梱包才数:1.2才 梱包重量:0.7kg ●光触媒
G-B G-GL ※光触媒加工商品ではございませんのでご注意ください。※光触媒加工商品ではございませんのでご注意ください。
G-TH G-PLP G-PK90 G-GH G-2TH G-MSG G-FR G-KSP ※特性上予告なく廃番になる事があります。 071 SOCIA
Office Green



オフィスの緑化でより快適なリラックス空間へ
G-WBDX

G-WBL

G-WBL
ウッドボックスL 90,200円(税抜) サイズ:W1000×D400×H400mm 花器サイズ:W910×D290×H400mm 葉 :ポリエステル+ポリエチレン 花 器:ウッド 入 数:1 梱包才数:3.8才 梱包重量:6.2kg ●光触媒 G-WBDX ウッドボックスDX 57,200円(税抜) サイズ:W900×D270×H270mm 花器サイズ:W900×D140×H200mm 葉 :ポリエステル+ポリエチレン 花 器:ウッド 入 数:1 梱包才数:3.8才 梱包重量:2.4kg ●光触媒
※特性上予告なく廃番になる事があります。 072
Garland Partition オフィスの緑化でより快適なリラックス空間へ
チェアデスク・収納パーティションテーブルレセプションロビーエクステリアアクセサリー木工

グリーン付き2連セット フレーム2連セット

G-TP2
ガーランドパーティション2連
99,800円(税抜)
サイズ:W1400×D22.2×H1500mm 本 体:スチ-ル 粉体塗装 葉 :ポリエステル+ポリエチレン 入 数:1(4個口) 梱包才数:3.6才 梱包重量:12kg
●連結可能 ●アジャスタ-付 ●G-AGL6個、 G-AG6個付

G-AGL
アイビーガーランドラージ 7,000円(税抜)
サイズ:L1800mm 葉 :ポリエステル+ポリエチレン 入 数:6
梱包才数:2.1才 梱包重量:2kg
●光触媒

ASO-SP3BLG+ASO-SP3BLG
パーティション2連
40,000円(税抜)
サイズ:W1400×D22.2×H1500mm 本 体:スチ-ル 粉体塗装 入 数:1(2個口) 梱包才数:1.2才 梱包重量:9.4kg ●連結可能 ●アジャスタ-付

ガーランドパーティションの設置注意点 ・2枚以上連結してご使用ください。単体では自立しません。 ・設置角度は90度〜 135度の範囲で設置してください。 ・ものを立て掛けたりしないでください。転倒する恐れがあります。
※特性上予告なく廃番になる事があります。
グリーン付き増設フレーム 増設フレーム

G-TP1
ガーランドパーティション1連
49,900円(税抜)
サイズ:W700×D22.2×H1500mm 本 体:スチ-ル 粉体塗装 葉 :ポリエステル+ポリエチレン 入 数:1(2個口) 梱包才数:1.8才 梱包重量:6kg
●連結可能 ●アジャスタ-付 ●G-AGL3個、 G-AG3個付

G-AG
斑入りアイビーガーランド 6,000円(税抜)
サイズ:L1800mm 葉 :ポリエステル+ポリエチレン 入 数:6 梱包才数:2.1才 梱包重量:2kg
●光触媒

ASO-SP3BLG
パーティション1連
20,000円(税抜)
サイズ:W700×D22.2×H1500mm 本 体:スチ-ル 粉体塗装 入 数:1 梱包才数:0.6才 梱包重量:4.7kg ●連結可能 ●アジャスタ-付
幼保レンタル・リース

G-AGL G-AG
073 SOCIA
Reception

CK H22

利便性に富んだ豊富な機能で 使用者の身体をしっかりサポートするメッシュチェア。
074
パーティション
Chair Desk / Storage
テーブル
Partition
レセプション
Table
ロビー
エクステリア
Lobby
アクセサリー
Exterior
Accessories Woodworking

オフィスチェア CKH22
チェアデスク・収納パーティションテーブルレセプションロビーエクステリアアクセサリー木工






ランバーサポートシンクロロッキング及び背固定機能
サイズ(mm)

梱包才数梱包重量
CKH22 45,300円 W520×D600×H1000〜1085(SH430〜515)6.1才19kg 仕様/張地:背/メッシュ(ポリエステル)座/布(ポリエステル) 脚:エンプラ樹脂成型品(ブラック) 入数:1 ●座昇降( ガスシリンダー式)機能付 ●シンクロロッキング機構付 ●背固定機能付 ●ランバーサポート付
オプション



肘可動(前後) 肘可動(上下) 肘可動(左右)
オプション肘 (左右セット) 価格(税抜) サイズ(mm)梱包才数梱包重量
CKH22-AR 9,800円 W94×D260×H3055.1才13kg 仕様/本体:ナイロン樹脂成型品(ブラック) パット:ポリウレタン樹脂成型品(ブラック) 入数:6 ●肘高さ調整機能付 ●肘前後調整機能付 ●肘角度調整機能付
■背・座カラーサンプル
背 BK:ブラック

座 BK:ブラック


体圧分散するクッションで 快適な座リ心地のチェア
座面クッションは適度な固さのあるモールド ウレタンを採用することにより、着座時の安 定性が向上して体圧分散と姿勢保持を両立し ています。


幼保レンタル・リース
オプションヘッドレスト 価格(税抜) サイズ(mm)梱包才数梱包重量
CKH22-HR 5,200円 W295×D100×H2182.2才6kg
仕様/本体:ナイロン樹脂成型品(ブラック) 生地:合成皮革 入数:6 ●ヘッドレスト高さ調整機能付
662 600 430 ~ 515 1000 ~ 1085 450 520 (座) 480 (背)
690 (肘) 662 615 650 430 ~ 515 645 ~ 802 11 75 ~ 1295 520 (座) 450 615 650 520 450 430 515 11 75 ~ 1295 662 600 430 515 1000 ~ 1085 690 (肘) 662 520 (座) 450 645 ~ 802 CKH22+CKH22-HR CKH22+CKH22-AR+CKH22-HR CKH22+CKH22-AR
CKH22-HR ヘッドレスト上下可動
CKH22
オフィスチェア メッシュ張り 価格(税抜)
CKH22(BK)
CKH22-AR
CKH22(BK)+CKH22-AR
CKH22(BK)+CKH22-AR+CKH22-HR
075 SOCIA

CK H11
背をしっかりサポート。
快適な座り心地のメッシュチェア。
 テーブル NOTK-2412(NA) P.207
SOCIA G-YK16 P.070
SOCIA ASO-S9060B(MAK) P.065
テーブル NOTK-2412(NA) P.207
SOCIA G-YK16 P.070
SOCIA ASO-S9060B(MAK) P.065
P.042
SOCIA ASO-W2411B(MAK)
CKH11(BK)+CKH11-AR 076
CKH11(BK)
オフィスチェア
CKH11
チェアデスク・収納パーティションテーブルレセプションロビーエクステリアアクセサリー木工

背面仕様

シンクロロッキング ロッキング時に身体の動きに合わせ、 背・座が連動して動き、適正な着座 姿勢を維持します。
オフィスチェア メッシュ張り 価格(税抜)

背固定機能 多段階に背もたれの角度を固定 できます。




ランバーサポート 標準装備のランバーサポートは、体格に 合わせて自由に調整でき、しっかりと身 体を支えることが可能です。
サイズ(mm) 梱包才数梱包重量
CKH11 44,000円 W490×D580×H1005〜1055 (SH435〜485)6.8才 14kg 仕様/張地:背・座/メッシュ (ポリエステル) 脚:エンプラ樹脂成型品 (ブラック) 入数:1 ●座昇降 (ガスシリンダ-式) 機能付 ●シンクロロッキング機構付 ●背 固定機能付 ●ランバ-サポ-ト (左右セパレ-ト式)



肘可動 オプション肘は体格に合わせて 高さを調整できます。 11段階で10mmピッチ

背・座メッシュ 背・座のポリエステルメッシュ素材が 快適な座り心地と、長時間着座時のム レを防ぎます。
幼保レンタル・リース
490 (座) 648 580 435 ~ 485 1005 ~ 1055 480 (背) 455 640 (肘) 648 580 435 ~ 485 1005 ~ 1055 490 (座) 455 600 ~ 731
オプション肘 (左右セット) 価格(税抜) サイズ(mm) 梱包才数梱包重量 CKH11-AR 7,800円 W84×D240×H269 3.4才 8.5kg 仕様/本体:ナイロン樹脂成型品 (ブラック) パット:ポリウレタン樹脂成型品 (ブラック) 入数:5(1個口) ●肘高さ調節機能付
CKH11(BK)
CKH11(BL)+CKH11-AR
CKH11
CKH11-AR
CKH11(BK)+CKH11-AR
CKH11+CKH11-AR
BL:ブルー BK:ブラック ■カラーサンプル
077 SOCIA

 デスク FDC-2412B P.204
テーブル ACS-900 P.139
パーティション MP-1809FAR
+MP-F×2
P.156
デスク FDC-2412B P.204
テーブル ACS-900 P.139
パーティション MP-1809FAR
+MP-F×2
P.156
CK01(BL) CK 01 078
CK01(BK)
オフィスチェア
CK01
チェアデスク・収納パーティションテーブルレセプションロビーエクステリアアクセサリー木工




オフィスチェア メッシュ張り 価格(税抜) サイズ(mm) 梱包才数梱包重量
CK01 42,700円 W490×D580×H970 1050 (SH415 495) 5.7才15kg
仕様/張地:背/メッシュ (ポリエステル) 座/布 (ポリエステル) 座:モ-ルドウレタン 脚:エンプラ樹脂成型品 (ブラック) 入数:1 ●座昇降 (ガスシリンダ-式) 機能付 ●シンクロロッキング機構付 ●ランバ-サポ-ト付

ランバーサポート
標準装備のランバーサポートは、体格に合わ せて自由に調整でき、しっかりと身体を支え ることが可能です。
オプション

シンクロロッキング
ロッキング時に身体の動きに合わせ、背・座が 連動して動き、適正な着座姿勢を維持します。


肘可動
オプション肘は体格に 合わせて高さを調整で きます。
11段階で10mmピッチ
オプション肘 (左右セット) 価格(税抜)サイズ(mm)梱包才数梱包重量
CK01-AR 8,000円 W80×D270×H2803.7才11kg
仕様/本体:ナイロン樹脂成型品 (ブラック) パット:ポリウレタン樹脂成型品 (ブラック) 入数:5 ●肘高さ調節機能付


GN:グリーン BL:ブルー BK:ブラック BK:ブラック BK:ブラック BK:ブラック





座クッション モールドウレタンによる立体的な成型で身 体にフィットしやすい形状になっています。



ガスシリンダー式座昇降機能 座面下のレバーを操作することでガス圧に より座の昇降が可能で、体格に合った高さ に調節できます。


ヘッドレスト可動 お好みの位置にヘッド レストを調整できます。
オプションヘッドレスト 価格(税抜)サイズ(mm)梱包才数梱包重量
CK01-HR 6,500円 W330×D140×H1802.2才5.7kg
幼保レンタル・リース
仕様/本体:ポリプロピレン樹脂成型品 (ブラック) 生地:布 (ポリエステル) 入数:5
●ヘッドレスト高さ調節機能付
490 (座) 647 580 415 ~ 495 970 ~ 1050 485 (背) 455 660 (肘) 647 590 415 ~ 495 620 ~ 794 1120 ~ 1245 490 (座) 455 660 (肘) 647 415 ~ 495 620 ~ 794 490 (座) 580 455 970 ~ 1050 647 590 415 ~ 495 11 20 ~ 1245 455 490 (座) 485 (背)
CK01(GR)+CK01-AR+CK01-HR
CK01(BL)+CK01-AR
CK01(GN)+CK01-HR
CK01-AR
CK01-HR
CK01 CK01+CK01-AR CK01+CK01-HR CK01 + CK01-AR+CK01-HR
CK01(BK) ブラック
BK:ブラック
GR:グレー
079 SOCIA
オフィスチェア

CK02



■カラーサンプル

ランバーサポート 標準装備のランバーサポートは、 体格に合わせて自由に調整でき、 しっかりと身体を支えることが 可能です。

シンクロロッキング ロッキング時に身体の動きに合 わせ、背・座が連動して動き、適正 な着座姿勢を維持します。


オフィスチェア メッシュ張り 価格(税抜) サイズ(mm) 梱包才数梱包重量
CK02 32,500円 W495×D580×H915 995 (SH410 490) 4.8才13kg
仕様/張地:背/メッシュ (ポリエステル) 座/布 (ポリエステル) 脚:エンプラ樹脂成型品 (ブラック) 入数:1 ●座昇降 (ガスシリンダ-式) 機能付 ●シンクロロッキング機構付 ●ランバ-サポ-ト付


肘可動
オプション肘は体格に合わせて 高さ調整が可能。 (9段階で9.4mmピッチ)
オプション肘 (左右セット) 価格(税抜)サイズ(mm)梱包才数梱包重量
CK02-AR 7,800円 W90×D240×H3103.6才11.5kg 仕様/本体:ナイロン樹脂成型品 (ブラック) パット:ポリウレタン樹脂成型品 (ブラック) 入数:5 ●肘高さ調節機能付









SL-AL(BK)
ループ型肘 価格(税抜)サイズ(mm)梱包才数梱包重量
SL-AL 6,300円 W195×D325×H2953.6才8kg 仕様/本体:樹脂成型品 入数:4
580 630 (肘) 495 (座) 460 606 410 ~ 490 620 ~ 700 915 ~ 995 580 680 (肘) 495 (座) 460 606 410 ~ 490 620 ~ 775 915 ~ 995
CK02-AR CK02 580 495 (座) 480 (背) 460 606 410 ~ 490 915 ~ 995
CK02+CK02-AR CK02+SL-AL
BK:ブラック
BK:ブラック
BL:ブルー
BK:ブラック
GR:グレー
GR:グレー
BK:ブラック
OR:オレンジ
CK02(BK)
CK02(BL)
CK02(GR) +CK02-AR
CK02(OR) +SL-AL
ASO-OC1(GN)
CK02(OR)
080
FDC-2412B(NA)
チェアデスク・収納パーティションテーブルレセプションロビーエクステリアアクセサリー木工

CK03




オフィスチェア メッシュ張り
価格(税抜)
サイズ(mm)
梱包才数梱包重量 CK03 30,000円 W490×D560×H915〜965(SH435〜485)4.4才12kg 仕様/張地:背・座/布(ポリエステル) 脚:エンプラ樹脂成型品(ブラック) 入数:1 ●座昇降(ガスシリンダー式)機能付 ●ロッキング機構付

SL-AL(BK)

オプション肘 (左右セット)
GN:グリーン BK:ブラック



体圧分散するクッションで 快適な座り心地のチェア 座面のクッションは適度な固さのある ウレタンを採用することにより、着座 時の安定性が向上して体圧分散と姿勢 保持を両立しています。
価格(税抜)サイズ(mm)梱包才数梱包重量
CK02-AR 7,800円 W90×D240×H3103.6才11.5kg
仕様/本体:ナイロン樹脂成型品 (ブラック) パット:ポリウレタン樹脂成型品 (ブラック) 入数:5 ●肘高さ調節機能付
ループ型肘 価格(税抜)サイズ(mm)梱包才数梱包重量 SL-AL 6,300円 W195×D325×H2953.6才8kg
仕様/本体:樹脂成型品 入数:4
幼保レンタル・リース
565 490 (座) 440 (背) 460 612 395 ~ 480 875 ~ 960 565 670 (肘) 490 (座) 460 612 395 ~ 480 625 ~ 785 87 5 ~ 960 565 640 (肘) 490 (座) 460 612 395 ~ 480 625 ~ 710 875 ~ 960 オフィスチェア
CK02-AR
CK03 CK03+CK02-AR CK03+SL-AL
CK03(BK)
CK03(GN)
CK03(BK) +CK02-AR
CK03(GN) +SL-AL
CoMbI。(DGR)+G-OVT16
CK03(GN)
ASO-M1575B(MAK)
081 SOCIA

LM1



オフィスチェア メッシュ張り 価格(税抜) サイズ(mm) 梱包才数梱包重量
LM1 28,400円 W480×D580×H820〜895 (SH405〜480) 4.5才12.5kg 仕様/張地:背/メッシュ (ポリエステル) 座/布 (ポリエステル) 脚:エンプラ樹脂成型品 (ブラック) 入数:1 ●座昇降 (ガス シリンダ-式) 機能付 ●ロッキング機構付
オプション肘

92AR


■カラーサンプル



オプション肘 (左右セット)
BK:ブラック BK:ブラック BL:ブルー BK:ブラック GN:グリーン BK:ブラック BK:ブラック GR:グレー





価格(税抜)サイズ(mm)梱包才数梱包重量 92AR 6,300円 W47×D298×H2552.8才11.5kg
仕様/本体:樹脂成型品 (ブラック) 入数:4 ●対応機種:ALPHA-G、K-921、 K-921PU、K-922、K-926、K-928、KOLーF1、LM1
610 405 ~ 480 820 ~ 895 580 445(背) 445 480 (座) 610 405 ~ 480 820 ~ 895 580 445 480 (座) 615 ~ 690 605 (肘) オフィスチェア
TPA-V1809B(BL)
LM1(BL)
LM1 LM1+92AR
LM1(GN)
LM1(BL)
LM1(BK)
082
LM1(GR)+92AR
オフィスチェア
チェアデスク・収納パーティションテーブルレセプションロビーエクステリアアクセサリー木工

KOL-F1 ラウンジやカジュアルシーンにも使いやすいオフィスチェア




オフィスチェア 価格(税抜) サイズ(mm) 梱包才数梱包重量
KOL-F1 39,800円 W460×D530×H850〜955 (SH410〜515)4.1才12.4kg 仕様/張地:布 脚:エンプラ樹脂成型品 (ブラック) 入数:1 ●座昇降 (ガスシリンダ-式) 機能付 ●背ロッキング機構付
オプション肘

オプション肘 (左右セット) 価格(税抜)サイズ(mm)梱包才数梱包重量 92AR 6,300円 W47×D298×H2552.8才11.5kg
仕様/本体:樹脂成型品 (ブラック) 入数:4 ●対応機種:ALPHA-G、K-921、 K-921PU、K-922、K-926、K-928、KOLーF1、LM1


幼保レンタル・リース
450 (座) 585 41 0 ~ 51 5 850 ~ 955 370 460 (背) 530 585 41 0 ~ 51 5 850 ~ 955 61 5 ~ 720 450 (座) 370 600 (肘) 530
KOL-F1(NV)
CFL-T80(IV)
KOL-F1(BR)
92AR KOL-F1 KOL-F1+92AR
KOL-F1(BR)
KOL-F1(NV)
KOL-F1(BR)+92AR
KOL-F1(NV)+92AR
NV:ネイビー BR:ブラウン
083 SOCIA
■カラーサンプル


オフィスチェア
ASO-W1111W(WH)
ASO-S9045B(MAK)
YSC01(GN) ASO-W1111W(WH)
YSC01(GR)
YSC01(BL)
S-DB(LBJ)+G-B
084
YSC01(GN) CoMbI。(DGR)+G-OVT16

YSC01
背もたれが使用者の動きに合わせて追従するスイングチェア。







チェアデスク・収納パーティションテーブルレセプションロビーエクステリアアクセサリー木工 幼保レンタル・リース



背スイング機構


背もたれがリクライニング時の身体の動きを横方向にも追従 することでソフトな座り心地を提供します。背スイング機構が 仕事の合間のリフレッシュタイムを快適にサポートします。

572 395 ~ 480 830 ~ 915 590 ~ 675 430 (座) 400 550 (肘) 540 572 395 ~ 480 830 ~ 915 430 (座) 400 440 (背) 540
K-921
スウィングチェア 価格(税抜) サイズ(mm) 梱包才数梱包重量 YSC01 29,800円 W440×D540×H830 915(SH395 480)3.9才 11kg 仕様/張地:布 脚:エンプラ樹脂成型品 入数:1 座昇降(ガスシリンダー式)機能付 背ロッキング機構付 背スイング機能付 オプション肘(左右 セット) 価格(税抜) サイズ(mm) 梱包才数梱包重量 YSC01-AR 6,300円 W52×D290×H272 1.9才 2.3kg 仕様/本体:樹脂成型品(ブラック) 入数:1 対応品番:YSC01
YSC01
オプション
BR:ブラウン BL:ブルー
GR:グレー GN:グリーン
BK:ブラック ■カラーサンプル
YSC01(GR)+YSC01-AR
YSC 01(BK)
YSC01(BL)
YSC01(BR)+YSC01-AR
YSC01(GN)+YSC01-AR
YSC01 YSC01+YSC01-AR
085 SOCIA
オフィスチェア

SKC-01


コンパクトな設計でW1000サイズの片袖デスクに すっきり収納できるオフィスチェア

オフィスチェア 価格(税抜) サイズ(mm) 梱包才数梱包重量
SKC-01 35,600円 W455×D550×H795〜900 (SH385〜490)3.3才 11kg 仕様/張地:布 背:モ-ルドウレタン 脚:エンプラ樹脂成型品 シェル:ポリプロピレン 入数:1 ●座昇降機能付 ●背ロッキング機構付 ●手掛け付
オプション


ループ型肘 価格(税抜)サイズ(mm) 梱包 才数 梱包 重量
SL-AL 6,300円 W195×D325×H295 3.6才8kg
仕様/本体:樹脂成型品 入数:4
T型肘 価格(税抜)サイズ(mm) 梱包 才数 梱包 重量
SL-AR 9,900円 W170×D240×H285 2.9才9.2kg
仕様/本体:樹脂成型品 パイプ:スチ-ル 入数:4

手掛け
手掛けを使うことで直接 張地に触れる機会を抑え、 クロスを汚さないつくり になっています。
■カラーサンプル(背・座 張地カラー)




ハンガー 価格(税抜)サイズ(mm) 梱包 才数 梱包 重量
SL-HG 3,400円 W420×D90×H175 1.3才4.8kg
仕様/本体:樹脂成型品 入数:4
540 795 ~ 900 385 ~ 490 430 550 455 540 795 ~ 900 450(座) 590(肘) 430 550 385 ~ 490 605 ~ 710 540 795 ~ 900 385 ~ 490 620 ~ 725 430 550 450(座) 650(肘)
SL-AL(BK)
SL-AR(BK)
SKC-01
SKC-01+SL-AR
SKC-01+SL-AL
SL-HG
BK:ブラック BL:ブルー OL:オリーブ
SKC-01(OL)+SL-AR(BK)
SKC-01(BL)+SL-AL(BK)
SKC-01(BK)
LDC-K107-R3(WH)
086
SKC-01(BL)

ALPHA-G


モールドウレタンを使用し体圧を分散させ 使用者の疲れを軽減するスイングチェア。

オフィスチェア 価格(税抜)
サイズ(mm) 梱包才数梱包重量 ALPHA-G 31,000円 W440×D570×H800〜930 (SH425〜555)4.2才12.3kg 仕様/張地:布 脚:エンプラ樹脂成型品 (グレ-) 背・座:モ-ルドウレタン 入数:1 ●座昇降 (ガスシリンダ-式) 機能付 ●背ロッキング機構付 ●背スウィング機能付
■カラーサンプル




オプション肘 (左右セット)
価格(税抜)サイズ(mm)梱包才数梱包重量 92AR(GR) 7,900円 W47×D298×H255 2.8才11.5kg 仕様/本体:樹脂成型品 (グレ-) 入数:4 ●対応機種:ALPHA-G、K-921、 K-921PU、K-922、K-926、K-928、KOLーF1、LM1
体圧分散

弊社従来品(チップウレタン)

ALPHA-G(モールドウレタン) ※色が赤く濃い部分ほど圧力がかかって います。
名古屋市工業研究所測定
幼保レンタル・リース
体圧分散するクッションで 快適な座り心地のチェア 適度な固さのあるモールドウレタンをお しりの形に合わせて成型しているので着 座時の安定性が向上して体圧分散と姿勢 保持を両立しています。
440 (座) 600 425 ~ 555 800 ~ 930 440 440 (背) 570 600 425 ~ 555 800 ~ 930 650 ~ 780 440 (座) 440 545 (肘) 570
ALPHA-G+92AR(GR) ALPHA-G 92AR(GR)
BK:ブラック BL:ブルー GN:グリーン
ALPHA-G(BK)
ALPHA-G(BL)
G-TN18
ALPHA-G(GN)+92AR(GR)
ASO-W2411B(MAK)
087 SOCIA
ALPHA-G(GN)
チェアデスク・収納パーティションテーブルレセプションロビーエクステリアアクセサリー木工
オフィスチェア

背もたれがリクライニング時の身体の動きを横方向にも追従 することでソフトな座り心地を提供します。背スイング機構が 仕事の合間のリフレッシュタイムを快適にサポートします。
K-921
PRO-4B
ASO-W2411B(SGR)
WJ-IN3(WH)
088
K-921(BL)
K-921
チェアデスク・収納パーティションテーブルレセプションロビーエクステリアアクセサリー木工

背もたれが使用者の動きに合わせて追従するスイングチェア。
■布カラーサンプル







BL:ブルー
BK:ブラック GN:グリーン
LBL:ライトブルー DGR:ダークグレー OR:オレンジ BR:ブラウン





K-921PU




オフィスチェア 価格(税抜) サイズ(mm) 梱包才数梱包重量
K-921 27,600円 W440×D570×H800~930 (SH425~555)4.2才 12.3kg 仕様/張地:布 脚:エンプラ樹脂成型品 (ブラック) 背:モ-ルドウレタン 入数:1 ●座昇降 (ガスシリンダ-式) 機能付 ●背ロッキング機構付 ●背スウィング機能付

■レザーカラーサンプル

BK:ブラック
背もたれが使用者の動きに合わせて追従 するスウィング機能があります。 (左右20度まで)
オフィスチェア 価格(税抜) サイズ(mm) 梱包才数梱包重量 K-921PU 28,100円 W440×D570×H800~930 (SH425~555)4.2才 12.3kg 仕様/張地:PU 脚:エンプラ樹脂成型品 (ブラック) 背:モ-ルドウレタン 入数:1 ●座昇降 (ガスシリンダ-式) 機能付 ●背ロッキング機構付 ●背スウィング機能付
幼保レンタル・リース
オプション肘 (左右セット)
価格(税抜)サイズ(mm)梱包才数梱包重量
92AR 6,300円 W47×D298×H2552.8才11.5kg 仕様/本体:樹脂成型品 (ブラック) 入数:4 ●対応機種:ALPHA-G、K-921、 K-921PU、K-922、K-926、K-928、KOLーF1、LM1
600 425 ~ 555 800 ~ 930 440 (座) 440 440 (背) 570 600 425 ~ 555 800 ~ 930 650 ~ 780 440 (座) 440 545 (肘) 570
92AR K-921/K-921PU K-921/K-921PU+92AR
K-921PU(BK)+92AR
K-921(BK)
K-921(BR)
K-921(GN)+92AR
K-921(DGR)
K-921(OR)+92AR
K-921(BL)
K-921(LBL)+92AR
089 SOCIA
オフィスチェア

K-922





オフィスチェア 価格(税抜) サイズ(mm) 梱包才数梱包重量
K-922 35,600円 W460×D530×H850〜955 (SH410〜515)4.0才12kg
仕様/張地:布 脚:エンプラ樹脂成型品 (ブラック) 入数:1 ●座昇降 (ガスシリンダ-式) 機能付 ●背ロッキング機構付
オプション肘



GN:グリーン BL:ブルー BK:ブラック


OR:オレンジ
オプション肘 (左右セット)
価格(税抜)サイズ(mm)梱包才数梱包重量 92AR 6,300円 W47×D298×H2552.8才11.5kg
仕様/本体:樹脂成型品 (ブラック) 入数:4 ●対応機種:ALPHA-G、K-921、 K-921PU、K-922、K-926、K-928、KOLーF1、LM1
450 (座) 585 41 0 ~ 51 5 850 ~ 955 370 460 (背) 530 585 41 0 ~ 51 5 850 ~ 955 61 5 ~ 720 450 (座) 370 600 (肘) 530
SOCIA ASO-W1811B(WH) P.042 K-922(GN)
K-922(BK)
K-922(BL)
K-922(GN)
K-922(OR)+92AR
K-922 K-922+92AR
92AR
■カラーサンプル
090
ASO-W2411B(SGR)
チェアデスク・収納パーティションテーブルレセプションロビーエクステリアアクセサリー木工

K-928



体圧分散

弊社従来品(チップウレタン)

K-928(モールドウレタン) ※色が赤く濃い部分ほど圧力がかかっています。
名古屋市工業研究所測定
体圧分散するクッションで快適な座り心地のチェア 適度な固さのあるモールドウレタンをおしりの形に合わせて成型して いるので着座時の安定性が向上して体圧分散と姿勢保持を両立 しています。


オフィスチェア 価格(税抜) サイズ(mm) 梱包才数梱包重量 K-928 26,000円 W440×D530×H745 875 (SH425 555)4.6才 11.2kg
仕様/張地:布 脚:エンプラ樹脂成型品 (ブラック) 座:モ-ルドウレタン 入数:1 ●座昇降 (ガスシリンダ-式) 機能付 ●背ロッキング機構付

オプション肘 (左右セット)
価格(税抜)サイズ(mm)梱包才数梱包重量 92AR 6,300円 W47×D298×H2552.8才11.5kg 仕様/本体:樹脂成型品 (ブラック) 入数:4 ●対応機種:ALPHA-G、K-921、 K-921PU、K-922、K-926、K-928、KOLーF1、LM1

■カラーサンプル

BL:ブルー BK:ブラック


GN:グリーン

幼保レンタル・リース


530 440(背/座) 425 600 745 ~ 875 425 ~ 555 530 440(背/座) 425 600 745 ~ 875 425 ~ 555 545 (肘) 650 ~ 780
K-928(BR)+92AR
K-928(BR)
K-928(BK)
K-928(LBL)
K-928(BL)
K-928(WN)+92AR
K-928 92AR K-928+92AR
K-928(GN)
WN:ワイン LBL:ライトブルー BR:ブラウン
091 SOCIA
オフィスチェア

ASO-OC1
■カラーサンプル



BL:ブルー GN:グリーン GR:グレー 背座一体型のコンパクトなチェアです。
ワークやミーティングなどあらゆるベースに。



チェア 価格(税抜) サイズ(mm) 梱包才数梱包重量
ASO-OC1 24,000円 W460×D500×H770〜845 (SH415〜490)3.9才 8kg 仕様/張地:布 (ポリエステル) 脚:スチ-ル 粉体塗装 (ブラック) 入数:1 ●座昇降 (ガスシリンダ-式) 機能付
500 460 365 526 770 ~ 845 415 ~ 490
ASO-OC1(BL)
ASO-OC1(GN)
ASO-OC1(GR)
ASO-OC1
QSB-1510O(BL-BL)
ASO-OC1(GR)
ASO-OC1(GR)
092
ASO-CF1260W(NA)
K-932




スタディチェア 価格(税抜)
チェアデスク・収納パーティションテーブルレセプションロビーエクステリアアクセサリー木工 幼保レンタル・リース
K-932(BK)成分値比較表
学校環境 衛生基準 当社製品
ホルムアルデヒド 100μg/㎥2.7μg/㎥
トルエン 260μg/㎥0.0μg/㎥
キシレン 870μg/㎥0.0μg/㎥
パラジクロロベンゼン 240μg/㎥0.0μg/㎥
エチルベンゼン 3800μg/㎥0.0μg/㎥
スチレン 220μg/㎥0.0μg/㎥
※シックハウス症候群の原因にもなるホルム アルデヒド、VOCの発生が極めて少ない原 材料を選んで製造しております
サイズ(mm) 梱包才数梱包重量
K-932 29,000円 W420×D500 530×H685 870 (SH410 515)2.8才8.4kg
仕様/張地:合成皮革 脚:エンプラ樹脂成型品 (ブラック) 入数:1 ●座昇降 (ガスシリンダ-式) 機能付 ●背高さ調節機能付 ●背スライド機能付 ※シックハウス症候群の原因にもなるホルムアルデヒド、 VOCの発生が極めて少ない原材料を選んで製造しております

■カラーサンプル


BK:ブラック BL:ブルー GR:グレー


オプション肘 (左右セット)
K-926



オフィスチェア 価格(税抜) サイズ(mm) 梱包才数梱包重量
K-926 16,600円 W440×D480〜515×H750〜880 (SH410〜540)2.0才 10kg 仕様/張地:布 脚:エンプラ樹脂成型品 (ブラック) 入数:1 ●座昇降 (ガスシリンダ-式) 機能付
価格(税抜)サイズ(mm)梱包才数梱包重量 92AR 6,300円 W47×D298×H2552.8才11.5kg
仕様/本体:樹脂成型品 (ブラック) 入数:4 ●対応機種:ALPHA-G、K-921、 K-921PU、K-922、K-926、K-928、KOLーF1、LM1
520 410 ~ 515 685 ~ 870 385(背) 420 (座) 380~410 500 530 525 410 ~ 540 750 ~ 880 390 (背) 440 (座) 365~400 480 515 525 410 ~ 540 750 ~ 880 610 ~ 740 440 (座) 365~400 545 (肘) 480~515
座昇降機能
背スライド機能
背高さ調節機能
K-926 K-926+92AR 92AR
K-932
K-932(BK)
K-926(GR)+92AR
K-926(BL)
K-926(BK)
093 SOCIA
K-926(GR)
HP-330







ワークスツール 価格(税抜) サイズ(mm) 梱包才数梱包重量
HP-330MS 16,000円 W375×D375×H420~5201.4才6kg
仕様/張地:布 脚:エンプラ樹脂成型品 (ブラック) 入数:1 ●座昇降 (ガスシリンダ-式) 機能付

ビニールレザー




ワークスツール 価格(税抜) サイズ(mm) 梱包才数梱包重量
HP-330LG 18,000円 W375×D375×H420~5201.4才6kg
仕様/張地:合成皮革 脚:エンプラ樹脂成型品 (ライトグレ-) 入数:1 ●座昇降 (ガスシリンダ-式) 機能付



ワークスツール 価格(税抜)
サイズ(mm) 梱包才数梱包重量
HP-330BK 16,000円 W375×D375×H420~5201.4才6kg
仕様/張地:合成皮革 脚:エンプラ樹脂成型品
460 420 ~ 520 375
(ブラック) 入数:1 ●座昇降 (ガスシリンダ-式) 機能付 スツール
HP-330MS(BK) ブラック HP-330MS(BL) ブルー
グリーン HP-330LG(LB) ライトブルー
HP-330MS(GN)
ピンク HP-330BK(BK) ブラック 布 GN:グリーン BL:ブルー BK:ブラック ■カラーサンプル PK:ピンク LB:ライトブルー ■カラーサンプル BK:ブラック ■カラーサンプル
HP-330LG(PK)
HP-330MS(BL)
HP-330MS(BK)
HP-330MS(GN)
CK01(BK)
HP-330LG(PK)
094
HP-330
キャスターチェア
KYシリーズ
チェアデスク・収納パーティションテーブルレセプションロビーエクステリアアクセサリー木工


キャスターチェア (背付) 価格(税抜) サイズ(mm) 梱包才数梱包重量
KY-B300 21,000円 W340×D465×H665~815 (SH480~640) 1.4才6.5kg 仕様/張地:合成皮革 (ポリウレタンレザ-) 脚:スチ-ル クロ-ムメッキ 背:スチ-ル クロ-ムメッキ 入数:1 ●座昇降 (ガスシリンダ-式) 機能付
■オプションキャスター(本体チェアのキャスターとは別売りです)






キャスターチェア (背付/背なし) 価格(税抜) サイズ(mm) 梱包才数梱包重量
KYB-B300 21,000円 W340×D465×H665~815 (SH480~640) 1.4才6.5kg
KYB-S300 17,500円 W320×D320×H480~6401.0才5kg
仕様/張地:合成皮革 (ポリウレタンレザ-) 脚:スチ-ル 背:スチ-ル 入数:1 ●座昇降 (ガスシリンダ-式) 機能付


凹凸のある座クッションはモールドウレタン。 ヘタらず滑り止め効果も期待できます。
キャスターチェア (背なし) 価格(税抜) サイズ(mm)梱包才数梱包重量
KY-S300 17,500円 W320×D320×H480~6401.0才5kg
仕様/張地:合成皮革 (ポリウレタンレザ-) 脚:スチ-ル クロ-ムメッキ 入数:1 ●座昇降 (ガスシリンダ- 式) 機能付
ナイロンキャスター 価格(税抜) サイズ(mm) 梱包才数梱包重量
OP-NY 2,200円 W56×D68×H59 1.1才11.5kg
仕様/本体:樹脂成型品(ブラック) 入数:20(1個口) ●価格は1台分(5個)の価格になります。
ウレタンキャスター 価格(税抜) サイズ(mm) 梱包才数梱包重量
OP-CPU 3,800円 W55×D70×H60 (※差し込み部除く)1.4才12.6kg
仕様/本体:樹脂成型品 (ブラック) ウレタン巻 入数:20 ●ウレタン製キャスタ-なので床を傷つけにくく、 スム-ズな移動が可能です。 ●価格は1台分 (5個) の価格になります。
プラパーツ 価格(税抜) サイズ(mm) 梱包才数梱包重量
OP-HP 2,000円 φ55×H57 (※差し込み部除く)1.1才7.8kg
仕様/本体:樹脂成型品 (ブラック) 入数:20 ●価格は1台分 (5個) の価格になります。
ゴムキャスター 価格(税抜) サイズ(mm) 梱包才数梱包重量
OP-CS 5,000円 W60×D33×H65 (※差し込み部除く)1.0才15.2kg 仕様/本体:スチ-ル キャスタ-:φ40mm双輪キャスタ- 入数:20 ●価格は1台分 (5個) の価格に なります。
■オプション肘・キャスター対応商品一覧(OFFICE)
共通項目 品番 オプション肘オプションキャスター 92AROP-CSOP-CPUOP-HPOP-NY ALPHA-G○※○○○○
ASO-OC1×○○○○
CK01 ×○○○○
CK02 ×○○○○
CK03 ×○○○○
CKH11×○○○○
CKH22×○○○○ ELETTA×○○○○ HP-330×○○○○
K-921/K-921PU ○○○○○
K-922 ○○○○○
K-926 ○○○○○
K-928 ○○○○○
K-932 ×○○○○
幼保レンタル・リース
KOL-F1○○○○○
KRM-430/430G ×○○○○
KYB-S300/KY-S300 ×○○○○
KYB-B300/KY-B300 ×○○○○
LM1 ○○○○○
MG-140H×○○○○ MG-140L×○○○○
PLC-120H×○○○○
PLC-120L×○○○○
SFIDA-C1××××× SKC-01×○○○○ オプション肘「92AR」のカラーはブラックになります。 ※ALPHA-Gにはシェルと同色(グレー)の肘も取り付け可能です。
φ320
KY-S300(BK)
KY-B300(BK)
KYB-B300
KYB-S300
OP-CPU
OP-NY
OP-HP
OP-CS
095 SOCIA
MG-140L

MG-140H/140L

マネジメント チェア 価格(税抜) サイズ(mm) 梱包才数梱包重量
MG-140H 82,000円 W650×D685×H1200~1270 (SH445~515) 8.9才28.5kg
仕様/張地:合成皮革 (ポリウレタンレザ-) 脚:アルミダイカスト 肘:アルミダイカスト 合成皮革 (ポリ塩化ビニ-
ル) 背・座:モ-ルドウレタン 入数:1 ●座昇降 (ガスシリンダ-式) 機能付 ●ロッキング機構付
厚みのあるクッションとダイキャストが 重厚感を醸し出すマネジメントチェア。

マネジメント チェア 価格(税抜) サイズ(mm) 梱包才数梱包重量
MG-140L 77,000円 W650×D685×H1000~1070 (SH445~515) 8.0才26.5kg 仕様/張地:合成皮革 (ポリウレタンレザ-) 脚:アルミダイカスト 肘:アルミダイカスト 合成皮革 (ポリ塩化ビニ- ル) 背・座:モ-ルドウレタン 入数:1 ●座昇降 (ガスシリンダ-式) 機能付 ●ロッキング機構付
650 (肘) 655 685 445 ~ 515 670 ~ 740 1200 ~ 1270 550 (座) 500 655 445 ~ 515 670 ~ 740 1000 ~ 1070 650 (肘) 685 550 (座) 500
マネージメントチェア
テーブル NOTD-2412(NA) P.207
MG-140H
MG-140H
MG-140L
MG-140L
SOCIA G-MS18 P.070 動画が 確認できます
096
オフィスチェア
チェアデスク・収納パーティションテーブルレセプションロビーエクステリアアクセサリー木工

PLC-120H/120L

オフィスチェア 価格(税抜) サイズ(mm) 梱包才数梱包重量
PLC-120H 52,000円 W600×D595×H1050~1125 (SH425~500) 7.9才16.5kg
仕様/張地:合成皮革 (ポリウレタンレザ-) 脚:スチ-ル クロ-ムメッキ 肘:スチ-ル クロ-ムメッキ 入数:1
●座昇降 (ガスシリンダ-式) 機能付 ●ロッキング機構付
デスク FDC-1212W(WH) P.205

幼保レンタル・リース
オフィスチェア 価格(税抜) サイズ(mm) 梱包才数梱包重量
PLC-120L 50,000円 W600×D595×H905~980 (SH425~500) 6.9才14.5kg
仕様/張地:合成皮革 (ポリウレタンレザ-) 脚:スチ-ル クロ-ムメッキ 肘:スチ-ル クロ-ムメッキ 入数:1 ●座昇降 (ガスシリンダ-式) 機能付 ●ロッキング機構付
425 ~ 500 650 ~ 725 1050 ~ 1125 600 (肘) 650 595 500 (座) 430 425 ~ 500 650 ~ 725 905 ~ 980 595 600 (肘) 595 500 (座) 430
PLC-120H
PLC-120H
PLC-120L
PLC-120L
097 SOCIA
PLC-120L
ロッキングチェア

ELETTA EL-8


CoMbI。(DGR)
アクセサリー NDS-100(BK) P.295
SOCIA ASO-ST4540B(SGR) P.049
自然なロッキング動作で前傾・後傾姿勢をとることができます。



ロッキング 前傾・後傾ともに7度まで、前後差最大で14度ロッ キングします。
座形状 座面にくぼみがあり、ロッキングによる体勢のズレや滑り を軽減する形状になっています。

背面仕様




エレッタ ロッキングチェア 価格(税抜) サイズ(mm)梱包才数梱包重量
EL-8 38,000円 W500×D615×H795 SH4007.9才15.5kg 仕様/張地:布 背:樹脂成型品(ブラック) 脚:スチール粉体塗装(ブラック) 入数:2(1個口) ●ロッキング機能付
615 500 420 (座) 445
400 795
GR:グレー DBL:ダークブルー BR:ブラウン ■カラーサンプル EL-8
EL-8(BR)
EL-8(DBL)
EL-8(GR)
G-OVT16
EL-8(BR)
EL-8(DBL)
098

ネスティングチェア

KRM-430G / KRM-430





ネスティングチェア 価格(税抜) サイズ(mm)
梱包才数梱包重量
アクセサリー NDS-100(BK) P.295
独自開発の背ロッキング機構で ミーティングを快適に。


KRM-430G 37,000円 W580×D575×H860 (SH430)9.9才18.7kg 仕様/張地:背/メッシュ 座/布 背:樹脂成型品 脚:スチ-ル 粉体塗装 (グレー) 入数:2 ●背ロッキング機 構付 ●平行スタッキング可能
20°





梱包才数梱包重量
KRM-430 37,000円 W580×D575×H860 (SH430)9.9才18.7kg 仕様/張地:背/メッシュ 座/布 背:樹脂成型品 脚:スチ-ル 粉体塗装 (ホワイト) 入数:2 ●背ロッキング 機構付 ●平行スタッキング可能
GR:グレー BL:ブルー BK:ブラック ■カラーサンプル
ロッキング 背が最大20°までロッキングします。 スタッキング 平行スタッキングにより効率よく収納でき ます。 535160 860 575 520(背) 450 (座) 455 430 580 スタッキング KRM-430G/KRM-430
GN:グリーン BL:ブルー BK:ブラック ■カラーサンプル
KRM-430G(BK)
KRM-430G(GR)
KRM-430(BL) KRM-430(GN)
KRM-430G(BL)
099 SOCIA
SOCIA ASO-T1575B(SGR) P.045
チェアデスク・収納パーティションテーブルレセプションロビーエクステリアアクセサリー木工 幼保レンタル・リース
ネスティングチェア

通気性のよいスリット加工の背もたれで快適なミーティングをサポートします。
ELETTA EL-6


動画が 確認できます ネスティング
ZRタイプ HSタイプ

エレッタネスティングチェア/

エレッタネスティングチェア/
■カラーサンプル(背カバー/座シート)




OR:オレンジ GN:グリーン BL:ブルー BK:ブラック
発注方法の説明 以下の記号を組合せて、チェアの種類及びカラーをお選びください。
品番 EL-6□-□□-□□ ①②③
①背樹脂カラー ③座シートカラー ②背カバーカラー ブラック B ホワイト W 布/ブラック BK 布/ブルー BL 布/グリーン GN 布/オレンジ OR 背カバーなし ZR ハンドルタイプ HS 布/ブラック BK 布/ブルー BL 布/グリーン GN 布/オレンジ OR
座シート、背カバーの取替えで簡単ECO! 背カバーはマジックテープで交換でき、座シートはシートごと交換が可能なので、汚れ た際はカバーやシートを取り替えるだけで、末永くお使いいただけます。

ELETTA用

ELETTA用
420 510 515 480 430 (座) 405 510195 820 スタッキング 420 510 515 480 430 (座) 405 510 195 820 スタッキング 420 510 515 480 430 (座) 405 510195 835 スタッキング
価格(税抜) EL-6□-HS-□□ 30,800円
(ハンドルタイプ)
30,800円
背カバー無 価格(税抜) EL-6□-ZR-□□
背カバー (各色) 価格(税抜) EL-CV 5,400円
価格(税抜)
円 EL-6□-□□-□□ EL-6□-ZR-□□ EL-6□-HS-□□
座シ-ト (各色)
EL-SN 9,200
EL-6B-ZR-OR ブラック-なし-オレンジ
EL-6B-HS-GN ブラック-なし-グリーン
平行スタッキング
EL-6B-HS-BL
EL-6W-HS-BK
100
デスク FDC-2412B(WH) P.204
ZRタイプ
EL-6B-ZR-BK ブラック-なし-ブラック

EL-6B-ZR-BL ブラック-なし-ブルー

エレッタネスティング チェア/背カバー無 価格(税抜) サイズ(mm) 梱包才数梱包重量
EL-6B-ZR-□□ 30,800円 W480×D515×H820 (SH420)10.0才12kg 仕様/張地:布 背:樹脂成型品 脚:スチ-ル (φ22.2mm) 粉体塗装 (シルバ-) 入数:2 ●平行スタッキング可能
EL-6B-ZR-GN ブラック-なし-グリーン

EL-6B-ZR-OR ブラック-なし-オレンジ

EL-6W-ZR-BK ホワイト-なし-ブラック

EL-6W-ZR-BL ホワイト-なし-ブルー

エレッタネスティング チェア/背カバー無 価格(税抜) サイズ(mm)梱包才数梱包重量
EL-6W-ZR-GN ホワイト-なし-グリーン

EL-6W-ZR-□□ 30,800円 W480×D515×H820 (SH420)10.0才12kg
仕様/張地:布 背:樹脂成型品 脚:スチ-ル (φ22.2mm) 粉体塗装 (シルバ-) 入数:2 ●平行スタッキング可能
HSタイプ
EL-6B-HS-BK ブラック-なし-ブラック

エレッタネスティング チェア/(ハンドルタイプ) 価格(税抜)
EL-6B-HS-BL ブラック-なし-ブルー

サイズ(mm)梱包才数梱包重量
EL-6B-HS-□□ 30,800円 W480×D515×H835 (SH420)12.0才12kg 仕様/張地:布 背:樹脂成型品 脚:スチ-ル (φ22.2mm) 粉体塗装 (シルバ-) 入数:2 ●平行スタッキング可能
EL-6W-HS-BK ホワイト-なし-ブラック

エレッタネスティング チェア/(ハンドルタイプ) 価格(税抜)
EL-6W-HS-BL ホワイト-なし-ブルー

サイズ(mm)梱包才数梱包重量
EL-6W-HS-□□ 30,800円 W480×D515×H835 (SH420)12.0才12kg 仕様/張地:布 背:樹脂成型品 脚:スチ-ル (φ22.2mm) 粉体塗装 (シルバ-) 入数:2 ●平行スタッキング可能
EL-6B-HS-GN ブラック-なし-グリーン

EL-6W-ZR-OR ホワイト-なし-オレンジ

EL-6B-HS-OR ブラック-なし-オレンジ

EL-6W-HS-GN ホワイト-なし-グリーン

幼保レンタル・リース
EL-6W-HS-OR ホワイト-なし-オレンジ

101 SOCIA
チェアデスク・収納パーティションテーブルレセプションロビーエクステリアアクセサリー木工
ネスティングチェア
ELETTA/背カバー付タイプ












エレッタネスティング チェア/背カバー付 価格(税抜)サイズ(mm) 梱包才数梱包重量
EL-6B-□□-□□ 33,500円 W480×D515×H820 (SH420) 10.0才12kg 仕様/張地:布 背:樹脂成型品 脚:スチ-ル (φ22.2mm) 粉体塗装 (シルバ-) 入数:2 ●平行スタッキング可能



エレッタネスティングチェア/ 背カバー付 価格(税抜) サイズ(mm) 梱包才数梱包重量
EL-6W-□□-□□ 33,500円 W480×D515×H820 (SH420)10.0才 12kg 仕様/張地:布 背:樹脂成型品 脚:スチ-ル (φ22.2mm) 粉体塗装 (シルバ-) 入数:2 ●平行スタッキング可能
EL-6B-BK-BK ブラック-ブラック-ブラック
EL-6B-BL-BL ブラック-ブルー-ブルー
EL-6B-GN-GN ブラック-グリーン-グリーン
EL-6B-OR-OR ブラック-オレンジ-オレンジ
EL-6B-BL-BK ブラック-ブルー-ブラック
EL-6B-GN-BK ブラック-グリーン-ブラック
EL-6B-OR-BK ブラック-オレンジ-ブラック
EL-6B-BK-BL ブラック-ブラック-ブルー
EL-6B-BK-GN ブラック-ブラック-グリーン
EL-6B-BK-OR ブラック-ブラック-オレンジ
EL-6W-BK-BK ホワイト-ブラック-ブラック
EL-6W-BL-BL ホワイト-ブルー-ブルー
EL-6W-GN-GN ホワイト-グリーン-グリーン
102
EL-6W-OR-OR ホワイト-オレンジ-オレンジ
ミーティングチェア
チェアデスク・収納パーティションテーブルレセプションロビーエクステリアアクセサリー木工

背はカバー付・カバー無・ハンドルの3種類。
背カバーと座シートはそれぞれ4色から組 み合わせができます。
ELETTA EL-4
ZRタイプ HSタイプ


■カラーサンプル(背カバー/座シート)


GN:グリーン BL:ブルー BK:ブラック


OR:オレンジ
発注方法の説明 以下の記号を組合せて、チェアの種類及びカラーをお選びください。
品番 EL-4□-□□-□□
①②③
①背樹脂カラー ③座シートカラー ②背カバーカラー
ブラック B ホワイト W 布/ブラック BK 布/ブルー BL 布/グリーン GN 布/オレンジ OR 背カバーなし ZR ハンドルタイプ HS
布/ブラック BK 布/ブルー BL 布/グリーン GN 布/オレンジ OR
座シート、背カバーの取替えで簡単ECO! 背カバーはマジックテープで交換でき、座シートはシートごと交換可能です。 汚れた際はカバーやシートを取り替えるだけ。


幼保レンタル・リース
430 810 625 495 460 (座) 470 1075 800 スタッキング/4脚 430 810 625 495 460 (座) 470 1075 800 スタッキング/4脚 430 810 625 495 460 (座) 487 1075 800 スタッキング/4脚
エレッタミーティングチェア/ 背カバーなし 価格(税抜) EL-4□-ZR-□□ 28,000円
エレッタミーティングチェア/ (ハンドルタイプ) 価格(税抜) EL-4□-HS-□□ 28,000円
ELETTA用 座シ-ト (各色) 価格(税抜) EL-ST 9,200円 ELETTA用 背カバー (各色) 価格(税抜) EL-CV 5,400円
EL-4□-□□-□□
EL-4□-HS-□□ EL-4□-ZR-□□
EL-4W-ZR-OR ホワイト-なし-オレンジ
EL-4W-HS-BK ホワイト-なし-ブラック
EL-4B-ZR-GN
103 SOCIA
ASO-W1111W(WH)
ZRタイプ
EL-4B-ZR-BK ブラック-なし-ブラック


EL-4B-ZR-BL ブラック-なし-ブルー
エレッタミーティング チェア/背カバーなし 価格(税抜) サイズ(mm)梱包才数梱包重量
EL-4B-ZR-□□ 28,000円 W495×D625×H810 (SH430)16.0才26kg 仕様/張地:布 背:樹脂成型品 脚:スチ-ル (φ22.2mm) 粉体塗装 (シルバ-) 入数:4
EL-4B-ZR-GN ブラック-なし-グリーン

EL-4B-ZR-OR ブラック-なし-オレンジ

EL-4W-ZR-BK ホワイト-なし-ブラック


EL-4W-ZR-BL ホワイト-なし-ブルー
エレッタミーティング チェア/背カバーなし 価格(税抜) サイズ(mm)梱包才数梱包重量
EL-4W-ZR-GN ホワイト-なし-グリーン

EL-4W-ZR-□□ 28,000円 W495×D625×H810 (SH430)17.0才26kg 仕様/張地:布 背:樹脂成型品 脚:スチ-ル (φ22.2mm) 粉体塗装 (シルバ-) 入数:4
HSタイプ
EL-4W-ZR-OR ホワイト-なし-オレンジ

EL-4B-HS-BK ブラック-なし-ブラック


EL-4B-HS-BL ブラック-なし-ブルー
エレッタミーティング チェア/(ハンドルタイプ) 価格(税抜) サイズ(mm)梱包才数梱包重量
EL-4B-HS-□□ 28,000円 W495×D625×H810 (SH430)17.0才25.6kg 仕様/張地:布 背:樹脂成型品 脚:スチ-ル (φ22.2mm) 粉体塗装 (シルバ-) 入数:4
EL-4W-HS-BK ホワイト-なし-ブラック

EL-4W-HS-BL ホワイト-なし-ブルー

エレッタミーティング チェア/(ハンドルタイプ) 価格(税抜) サイズ(mm)梱包才数梱包重量
EL-4W-HS-□□ 28,000円 W495×D625×H810 (SH430)17.0才25.6kg 仕様/張地:布 背:樹脂成型品 脚:スチ-ル (φ22.2mm) 粉体塗装 (シルバ-) 入数:4
EL-4B-HS-GN ブラック-なし-グリーン

EL-4B-HS-OR ブラック-なし-オレンジ

EL-4W-HS-GN ホワイト-なし-グリーン

EL-4W-HS-OR ホワイト-なし-オレンジ

104
ミーティングチェア
ELETTA/背カバー付
チェアデスク・収納パーティションテーブルレセプションロビーエクステリアアクセサリー木工

EL-4B-BK-BK ブラック-ブラック-ブラック

EL-4B-BL-BL ブラック-ブルー-ブルー





EL-4B-GN-GN ブラック-グリーン-グリーン





エレッタミーティングチェア/ 背カバー付 価格(税抜)サイズ(mm) 梱包才数梱包重量
EL-4B-□□-□□ 31,700円 W495×D625×H810 (SH430) 16.0才26kg 仕様/張地:布 背:樹脂成型品 脚:スチ-ル (φ22.2mm) 粉体塗装 (シルバ-) 入数:4

幼保レンタル・リース

エレッタミーティングチェア/ 背カバー付 価格(税抜) サイズ(mm) 梱包才数梱包重量
EL-4W-□□-□□ 31,700円 W495×D625×H810 (SH430)16.0才 26kg 仕様/張地:布 背:樹脂成型品 脚:スチ-ル (φ22.2mm) 粉体塗装 (シルバ-) 入数:4
EL-4B-OR-OR ブラック-オレンジー-オレンジ
EL-4B-BL-BK ブラック-ブルー-ブラック
EL-4B-GN-BK ブラック-グリーン-ブラック
EL-4B-OR-BK ブラック-オレンジ-ブラック
EL-4B-BK-BL ブラック-ブラック-ブルー
EL-4B-BK-GN ブラック-ブラック-グリーン
EL-4B-BK-OR ブラック-ブラック-オレンジ
EL-4W-BK-BK ホワイト-ブラック-ブラック
EL-4W-BL-BL ホワイト-ブルー-ブルー
EL-4W-GN-GN ホワイト-グリーン-グリーン
EL-4W-OR-OR ホワイト-オレンジー-オレンジ
105 SOCIA
ミーティングチェア

SFIDA-C1



スフィーダキャスターチェア 価格(税抜) サイズ(mm) 梱包才数梱包重量
SFIDA-C1 23,500円 W490×D560×H775 (SH430)12.1才 28kg 仕様/張地:合成皮革 背:樹脂成型品 (ライトグレ-) 脚:スチ-ル 粉体塗装 (シルバ-) 入数:4 ●スタッキング可能 (4脚まで)




430 775 560 925 660 490 425 (座) 437 スタッキング/4脚
SFIDA-C1
SFIDA-C1(BL)
SFIDA-C1(GN)
SFIDA-C1(OR)
スタッキング例
テーブル BA-4MV(WH) P.211
SFIDA-C1(OR)
OR:オレンジ GN:グリーン BL:ブルー ■カラーサンプル 106
SFIDA-C1(GN)
スタッキングチェア
チェアデスク・収納パーティションテーブルレセプションロビーエクステリアアクセサリー木工

SFIDA-B




スフィーダミーティングチェア 価格(税抜) サイズ(mm) 梱包才数梱包重量
SFIDA-B 18,000円 W515×D550×H775 (SH430)11.0才21kg
仕様/張地:合成皮革 背:樹脂成型品 (ブラック) 脚:スチ-ル 粉体塗装 (ブラック) 入数:4 ●スタッキング可能 (4脚まで)
スタッキング例 チェア台車
■カラーサンプル







連結プラパート SFIDAは横に複数台並べた際、きれいに並べることが出 来るよう、標準で連結プラパートが取り付けられています。

幼保レンタル・リース
マッキンリー台車 (25台用) 価格(税抜)サイズ(mm)梱包才数梱包重量
MAC-25 82,000円 W550×D925×H84017.4才10kg
仕様/フレ-ム:スチ-ル (φ25.4mm) メラミン焼付塗装 入数:1 ●キャスタ-:サ-モプラスチックエラストマ - (ストッパ-付2個、ストッパ-無2個) ●最大積載数25脚 (SFIDA積載時/W550×D1080×H1530mm・ MK-480積載時/W550×D1015×H1600mm ) ●対応機種:SFIDA、SFIDA-B、MK-480
430 775 550 855 630 515 425 (座) 437 スタッキング/4脚
SFIDA-B
MAC-25
SFIDA-B(12台)積載時
SFIDA-B(25台)積載時
1080 1530
SFIDA-B(BK)
SFIDA-B(BL)
SFIDA-B(GN)
SFIDA-B(OR)
OR:オレンジ GN:グリーン BL:ブルー BK:ブラック
107 SOCIA
ミーティングチェア

SFIDA





スフィーダミーティングチェア 価格(税抜) サイズ(mm) 梱包才数梱包重量
SFIDA 18,000円 W515×D550×H775 (SH430)11.0才21kg
仕様/張地:合成皮革 背:樹脂成型品 (ライトグレ-) 脚:スチ-ル 粉体塗装 (シルバ-) 入数:4 ●スタッキング可能 (4脚まで)
スタッキング例







連結プラパート SFIDAは横に複数台並べた際、きれいに並べることが出 来るよう、標準で連結プラパートが取り付けられています。
チェア台車

マッキンリー台車 (25台用) 価格(税抜)サイズ(mm)梱包才数梱包重量 MAC-25 82,000円 W550×D925×H84017.4才10kg 仕様/フレ-ム:スチ-ル (φ25.4mm) メラミン焼付塗装 入数:1 ●キャスタ-:サ-モプラスチックエラストマ - (ストッパ-付2個、ストッパ-無2個) ●最大積載数25脚 (SFIDA積載時/W550×D1080×H1530mm・ MK-480積載時/W550×D1015×H1600mm ) ●対応機種:SFIDA、SFIDA-B、MK-480
1080 1530 430 775 550 855 630 515 425 (座) 437 スタッキング/4脚
SFIDA
SFIDA(BK) SFIDA(BL)
SFIDA(GN) SFIDA(OR) 背面仕様
MAC-25 SFIDA(12台)積載時
SFIDA(25台)積載時
OR:オレンジ GN:グリーン BL:ブルー BK:ブラック
■カラーサンプル
108
スタッキングチェア
MK-480
チェアデスク・収納パーティションテーブルレセプションロビーエクステリアアクセサリー木工




マッキンリースタッキングチェア 価格(税抜) サイズ(mm) 梱包才数梱包重量
MK-480 25,800円 W485×D530×H745 (SH400)9.9才 21kg
仕様/張地:合成皮革 脚:スチ-ル (φ13mm) クロ-ムメッキ 入数:4 ●スタッキング可能 (4脚まで) ●連結仕様も対応可能です
■カラーサンプル





メモ台 価格(税抜) サイズ(mm) 梱包才数梱包重量
MEO-305 45,000円 W95~305×D310×H680~9003.0才 9.8kg
仕様/天板:低圧メラミン化粧板 ソフトエッジ フレ-ム:アルミ 粉体塗装 (シルバ-) パイプ径:φ12.7㎜・φ13㎜ 入数:2
チェア台車



連結仕様も対応可能です。 ※別途お見積もりいたします。


ロックレバー 脚フレームにしっかり固定で きます。


位置調節 ダイヤルで調整することが 可能です 荷掛け

幼保レンタル・リース
マッキンリー台車 (25台用) 価格(税抜)サイズ(mm)梱包才数梱包重量 MAC-25 82,000円 W550×D925×H84017.4才10kg 仕様/フレ-ム:スチ-ル (φ25.4mm) メラミン焼付塗装 入数:1 ●キャスタ-:サ-モプラスチックエラストマ - (ストッパ-付2個、ストッパ-無2個) ●最大積載数25脚 (SFIDA積載時/W550×D1080×H1530mm・ MK-480積載時/W550×D1015×H1600mm ) ●対応機種:SFIDA、SFIDA-B、MK-480
400 745 530 845 630 485 420 (座) 430 スタッキング/4脚 925 840 555 355 550 1080 1530 1015 1600
MK-480(BK)
MAC-25
MK-480(BL)
MK-480(WH)
MK-480
スタッキング例
MK-480(BK)+MEO-305
跳ね上げ時 ポイント
MAC-25 MK-480(12台)積載時
MAC-25 SFIDA(12台)積載時 MK-480(12台)積載時 SFIDA(12台)積載時
WH:ホワイト BL:ブルー BK:ブラック
MAC-25 109 SOCIA
木製チェア
均質な木目の美しさと丈夫なタモ材を使用した リフレッシュチェアです。

ASO-WC2T/WC2F-NA



タモ -Ashタモ材 やや重みがあり割れや反りが少ない、ペンキ やステインがよく馴染み、つや出し加工で美し く仕上がる。加工性も良く釘打ちやネジ、接 着の強度が保たれる。古くから高級家具や工 芸用材として用いられた銘木の一つ。
GJ:グレージュ ■カラーサンプル




※製法の特性上、繊維の流れる方向により、色が異なって見えることがあります。
スペイン製 Fabric




木製チェア 価格(税抜) サイズ(mm) 梱包才数梱包重量 ASO-WC2T 38,000円 W445×D475×H765 (SH415) 10.4才 12kg 仕様/フレ-ム:天然木 (タモ材) ポリウレタン塗装 座:成型合板 突板貼り (タモ材) ポリウレタン塗装 入数:2(1個口)
木製チェア 価格(税抜) サイズ(mm) 梱包才数梱包重量
仕様/フレ-ム:天然木 (タモ材) ウレタン塗装 座:成型合板 突板貼り (タモ材) ポリウレタン塗装 張地:布 (ポリエステル) 入数:2(1個口)




水を加えるだけで汚れが浮 き上がります。 被膜により、汚れが繊維に 浸透するのを防ぎます。



生地にこぼれた汚れをとりのぞきま す。
アクアクリーン加工により、 繊維全てが目に見えない分 子被膜で覆われています。 汚れを直接、または水で湿らせた 吸水性の高い布で濡らし、数秒待 ちます。 汚れに布を押し当て、円を描くよう に生地を優しくこすります。
布で拭き取るだけで汚れが 落とせます。
475 440(背) 390 765 450 445(座) 475 440(背) 390 765 415 445(座)
ASO-WC2F-NA 51,000
10.4才 14kg
円 W445×D475×H765 (SH450)
ASO-WC2F-NA
ASO-WC2T
ASO-WC2T(NA) 背面仕様
ASO-WC2F-NA(GJ)
ASO-WC2F-NA(MS)
ASO-WC2F-NA(TQ)
ASO-WC2F-NA(WH)
WH:ホワイト TQ:ターコイズ MS:マスタード
110
木製チェア
チェアデスク・収納パーティションテーブルレセプションロビーエクステリアアクセサリー木工





座幅を広くとった設計でゆったりとした 座り心地の良い木製チェア。


■カラーサンプル タモ材 やや重みがあり割れや反りが少 ない、ペンキやステインがよく馴 染み、つや出し加工で美しく仕 上がる。加工性も良く釘打ちや ネジ、接着の強度が保たれる。 古くから高級家具や工芸用材と して用いられた銘木の一つ。

BL:ブルー


木製チェア 価格(税抜) サイズ(mm) 梱包才数梱包重量
ASO-WC1 41,000円 W470×D560×H765 (SH440)11.9才15.5kg
仕様/張地:布 (ポリエステル) フレ-ム:天然木 (タモ材) ポリウレタン塗装 入数:2(1個口)
別張りでシーンに合ったカラーにできる木製チェア。



■カラーサンプル




木製チェア 価格(税抜) サイズ(mm) 梱包才数梱包重量
ASO-WC1 58,000円 W470×D560×H765 (SH440)11.9才15.5kg
仕様/張地:布 フレ-ム:天然木 (タモ材)
品名 図番 ASO-WC1 縮尺 560 470 420 765 440
ポリウレタン塗装 入数:2(1個口) IV:アイボリー LGR:ライトグレー BR:ブラウン
ASO-WC1(別張りLGR)
ASO-WC1(IV)
ASO-WC1(別張りBR)
ASO-WC1(BL)
ASO-CF750B(NA)
ASO-WC1(IV)
ASO-CF750W(NA)
111 SOCIA
ASO-WC1
幼保レンタル・リース
ミーティングチェア

ALES
※ALES、ALES-Bのみ
発注方法の説明
新しいカラーの追加で選べるバリエーションは全部で144パターン。
①は合板カラー、②はパッドカラー、末尾の「B」は黒塗装脚となります、ご注意ください。
品番 ALES-□(パッド無 メッキ脚)
①合板色 ブラウン → BR ナチュラル → NA チェリー → CH オーク → AK 注意事項をご確認の上、下記のリストに従い、お好みのカラーをお選びください。
品番 ALES-□-B(パッド無 黒塗装脚)
品番 ALES-P-□-□(パッド付 メッキ脚)
品番 ALES-P-□-□-B(パッド付 黒塗装脚) ① ① ① ① ② ②

チェアパッドなし メッキ脚 価格(税抜) サイズ(mm)

梱包才数梱包重量
ALES-□ 25,700円 W505×D505×H855 (SH440)12.8才17kg
仕様/背・座:成型合板 メラミン化粧貼り フレ-ム:スチ-ル (φ15.9mm) 入数:4
●スタッキング可能 (4脚まで)









※注意事項 パッド付は張地の種類によって価格が異なります。 お間違えのなきようカラーをお選びください。
合成皮革(Nタイプ) ブラック → BK ブラウン → BR アイボリー → IV 合成皮革(Gタイプ) アクア → GAQ ライム → GLM イエロー → GYE

②張地カラー
合成皮革(Cタイプ)NEW ベージュ → CBJ グリーン → CGN ブラック → CBK ネイビー → CNV ブラウン → CBR
布 ブラック → FBK グリーン → FGN ブルー → FBL マスタード → FMS ブラウン → FBR ピンク → FPK

チェアパッドなし 黒塗装脚 価格(税抜) サイズ(mm) 梱包才数梱包重量
ALES-□-B 25,700円 W505×D505×H855 (SH440)12.8才17kg
仕様/背・座:成型合板 メラミン化粧貼り フレ-ム:スチ-ル (φ15.9mm) 入数:4 ●スタッキング可能 (4脚まで)











 ALES-NA ナチュラル
ALES-BR ブラウン
ALES-AK-B オーク
ALES-CH-B チェリー
ALES-NA
ALES-NA
ALES-NA ナチュラル
ALES-BR ブラウン
ALES-AK-B オーク
ALES-CH-B チェリー
ALES-NA
ALES-NA
FMS:マスタード FGN:グリーン FBR:ブラウン FBL:ブルー FBK:ブラック FPK:ピンク 張地(布) CNV:ネイビー CGN:グリーン CBR:ブラウン CBK:ブラック CBJ:ベージュ GYE:イエロー GLM:ライム GAQ:アクア 張地(Cタイプ) 張地(Gタイプ) 合板 AK:オーク NA:ナチュラル CH:チェリー BR:ブラウン BK:ブラック IV:アイボリー BR:ブラウン 張地(Nタイプ) ■カラーサンプル 112

合皮(Cタイプ)
メッキ脚 塗装脚
チェアデスク・収納パーティションテーブルレセプションロビーエクステリアアクセサリー木工

ALES-P-AK-CBR オーク-ブラウン

ALES-P-BR-CBJ ブラウン-ベージュ
チェアパッド付メッキ脚 価格(税抜) サイズ(mm) 梱包才数梱包重量
ALES-P-□□-□□□ 32,000円 W505×D505×H855 (SH460)13.3才19kg
仕様/背・座:成型合板 メラミン化粧貼り・背・座:成型合板 メラミン化粧貼り フレ-ム:スチ-ル (φ15.9 mm) 張地:合成皮革 入数:4 ●スタッキング不可
合皮(Nタイプ)

ALES-P-CH-CNV-B チェリー-ネイビー

ALES-P-NA-CGN-B ナチュラル-グリーン
チェアパッド付黒塗装脚 価格(税抜) サイズ(mm)梱包才数梱包重量 ALES-P-□□-□□□-B 32,000円 W505×D505×H855 (SH460)13.3才19kg
仕様/背・座:成型合板 メラミン化粧貼り フレ-ム:スチ-ル (φ15.9 mm) 張地:合成皮革 入数:4 ●スタッキング不可
塗装脚 メッキ脚
ALES-P-BR-BK ブラウン-ブラック

ALES-P-NA-IV ナチュラル-アイボリー

チェアパッド付メッキ脚 価格(税抜) サイズ(mm)梱包才数梱包重量
ALES-P-□□-□□ 29,800円 W505×D505×H855 (SH460)13.3才19kg 仕様/背・座:成型合板 メラミン化粧貼り フレ-ム:スチ-ル (φ15.9mm) 張地:合成皮革 入数:4 ●スタッキング不可
合皮(Gタイプ)
ALES-P-AK-IV-B オーク-アイボリー


ALES-P-CH-BR-B チェリー-ブラウン
チェアパッド付黒塗装脚 価格(税抜) サイズ(mm)梱包才数梱包重量 ALES-P-□□-□□-B 29,800円 W505×D505×H855 (SH460)13.3才19kg 仕様/背・座:成型合板 メラミン化粧貼り フレ-ム:スチ-ル (φ15.9mm) 張地:合成皮革 入数:4 ●スタッキング不可
布張り

ALES-P-NA-GAQ ナチュラル-アクア

メッキ脚 塗装脚 塗装脚 メッキ脚
ALES-P-NA-GLM-B ナチュラル-ライム
チェアパッド付メッキ脚 価格(税抜) サイズ(mm)梱包才数梱包重量
ALES-P-□□-□□□ 36,400円 W505×D505×H855 (SH460)13.3才19kg 仕様/背・座:成型合板 メラミン化粧貼り フレ-ム:スチ-ル (φ15.9mm) 張地:合成皮革 (抗菌仕様) 入数:4 ●スタッキング不可
チェアパッド付黒塗装脚 価格(税抜) サイズ(mm)梱包才数梱包重量
ALES-P-□□-□□□-B 36,400円 W505×D505×H855 (SH460)13.3才19kg 仕様/背・座:成型合板 メラミン化粧貼り フレ-ム:スチ-ル (φ15.9mm) 張地:合成皮革 (抗菌仕様) 入数:4 ●スタッキング不可

ALES-P-CH-FGN チェリー-グリーン

ALES-P-AK-FMS-B オーク-マスタード
チェアパッド付メッキ脚 価格(税抜) サイズ(mm)梱包才数梱包重量
ALES-P-□□-□□□ 33,900円 W505×D505×H855 (SH460)13.3才19kg 仕様/背・座:成型合板 メラミン化粧貼り フレ-ム:スチ-ル (φ15.9mm) 張地:布 入数:4 ●スタッキング不可
幼保レンタル・リース
チェアパッド付黒塗装脚 価格(税抜) サイズ(mm)梱包才数梱包重量
ALES-P-□□-□□□-B 33,900円 W505×D505×H855 (SH460)13.3才19kg 仕様/背・座:成型合板 メラミン化粧貼り フレ-ム:スチ-ル (φ15.9mm) 張地:布 入数:4 ●スタッキング不可
420 (座) 430 505 505 440 855 595 1000 スタッキング/4脚 420 (座) 430 505 505 460 855
ALES ALES-P 113 SOCIA
ALES-HP-BR-FBL

ALES-H
※ALES-H、ALES-H-Bのみ
発注方法の説明
ALES-HP-NA-FMS
便利なフック付きチェア。
使いやすい形でバッグやリュックを掛けることができます。
注意事項をご確認の上、下記のリストに従い、お好みのカラーをお選びください。
①は合板カラー、②はパッドカラー、末尾の「B」は黒塗装脚となります、ご注意ください。
品番 ALES-H-□(パッド無 メッキ脚)
品番 ALES-H-□-B(パッド無 黒塗装脚)
品番 ALES-HP-□-□(パッド付 メッキ脚)
品番 ALES-HP-□-□-B(パッド付 黒塗装脚) ① ① ① ① ② ②


チェアパッドなし メッキ脚 価格(税抜) サイズ(mm)梱包才数梱包重量
ALES-H-□□ 25,700円 W505×D505×H855 (SH440)12.8才17kg
仕様/背・座:成型合板 メラミン化粧貼り フレ-ム:スチ-ル (φ15.9mm) 入数:4 ●スタッキング可能 (4脚まで)
■カラーサンプル










※注意事項 パッド付は張地の種類によって価格が異なります。 お間違えのなきようカラーをお選びください。
①合板色 ②張地カラー ブラウン → BR ナチュラル → NA 合成皮革(Nタイプ) ブラック → BK ブラウン → BR アイボリー → IV 合成皮革(Gタイプ) アクア → GAQ ライム → GLM イエロー → GYE
合成皮革(Cタイプ)NEW ベージュ → CBJ グリーン → CGN ブラック → CBK ネイビー → CNV ブラウン → CBR
布 ブラック → FBK グリーン → FGN ブルー → FBL マスタード → FMS ブラウン → FBR ピンク → FPK


チェアパッドなし 黒塗装脚 価格(税抜) サイズ(mm)梱包才数梱包重量
ALES-H-□□-B 25,700円 W505×D505×H855 (SH440)12.8才17kg
仕様/背・座:成型合板 メラミン化粧貼り フレ-ム:スチ-ル (φ15.9mm) 入数:4 ●スタッキング可能 (4脚まで)








 ALES-H(NA) ナチュラル
ALES-H(BR) ブラウン
ALES-H-NA-B ナチュラル
ALES-H(NA) ナチュラル
ALES-H(BR) ブラウン
ALES-H-NA-B ナチュラル
チェア
ALES-H-BR-B ブラウン
SOCIA ASO-M1890B(BR) P.045
FMS:マスタード FGN:グリーン FBR:ブラウン FBL:ブルー FBK:ブラック FPK:ピンク CBJ:ベージュ GYE:イエロー GLM:ライム GAQ:アクア 張地(Cタイプ) 張地(Gタイプ) 合板 BR:ブラウン BK:ブラック IV:アイボリー BR:ブラウン 張地(Nタイプ)
NA:ナチュラル
114

合皮(Cタイプ)
チェアデスク・収納パーティションテーブルレセプションロビーエクステリアアクセサリー木工
ALES-HP-BR-CNV ブラウン-ネイビー


ALES-HP-NA-CBK ナチュラル-ブラック
チェアパッド付メッキ脚 価格(税抜) サイズ(mm)梱包才数梱包重量
ALES-HP-□□-□□□ 32,000円 W505×D505×H855 (SH460)13.3才19kg 仕様/背・座:成型合板 メラミン化粧貼り・背・座:成型合板 メラミン化粧貼り フレ-ム:スチ-ル (φ15.9 mm) 張地:合成皮革 入数:4 ●スタッキング不可
合皮(Nタイプ)
メッキ脚 塗装脚 塗装脚
ALES-HP-BR-CBJ-B ブラウン-ベージュ

ALES-HP-NA-CBR-B ナチュラル-ブラウン

チェアパッド付黒塗装脚 価格(税抜) サイズ(mm)梱包才数梱包重量
ALES-HP-□□-□□□-B 32,000円 W505×D505×H855 (SH460)13.3才19kg 仕様/背・座:成型合板 メラミン化粧貼り フレ-ム:スチ-ル (φ15.9 mm) 張地:合成皮革 入数:4 ●スタッキング不可

ALES-HP-BR-IV ブラウン-アイボリー

ALES-HP-NA-BR ナチュラル-ブラウン
チェア (パッド付) 価格(税抜) サイズ(mm)梱包才数梱包重量
ALES-HP-□□-□□ 29,800円 W505×D505×H855 (SH460)13.3才19kg
仕様/背・座:成型合板 メラミン化粧貼り フレ-ム:スチ-ル (φ15.9mm) 張地:合成皮革 入数:4
●スタッキング不可

ALES-HP-BR-BK-B ブラウン-ブラック
メッキ脚 塗装脚 メッキ脚 塗装脚 メッキ脚
ALES-HP-NA-IV-B ナチュラル-アイボリー

チェアパッド付黒塗装脚 価格(税抜) サイズ(mm)梱包才数梱包重量
ALES-HP-□□-□□-B 29,800円 W505×D505×H855 (SH460)13.3才19kg 仕様/背・座:成型合板 メラミン化粧貼り フレ-ム:スチ-ル (φ15.9mm) 張地:合成皮革 入数:4 ●スタッキング不可
合皮(Gタイプ) 布張り
ALES-HP-NA-GAQ ナチュラル-アクア

ALES-HP-NA-GYE-B ナチュラル-イエロー

チェアパッド付メッキ脚 価格(税抜) サイズ(mm)梱包才数梱包重量
ALES-HP-□□-□□□ 36,400円 W505×D505×H855 (SH460)13.3才19kg 仕様/背・座:成型合板 メラミン化粧貼り フレ-ム:スチ-ル (φ15.9mm) 張地:合成皮革 (抗菌仕様) 入数:4 ●スタッキング不可
チェアパッド付黒塗装脚 価格(税抜) サイズ(mm)梱包才数梱包重量
ALES-HP-□□-□□□-B 36,400円 W505×D505×H855 (SH460)13.3才19kg 仕様/背・座:成型合板 メラミン化粧貼り フレ-ム:スチ-ル (φ15.9mm) 張地:合成皮革 (抗菌仕様) 入数:4 ●スタッキング不可

ALES-HP-NA-FPK ナチュラル-ピンク
ALES-HP-BR-FBK-B ブラック-ブラック

チェアパッド付メッキ脚 価格(税抜) サイズ(mm)梱包才数梱包重量
ALES-HP-□□-□□□ 33,900円 W505×D505×H855 (SH460)13.3才19kg 仕様/背・座:成型合板 メラミン化粧貼り フレ-ム:スチ-ル (φ15.9mm) 張地:布 入数:4 ●スタッキング不可
幼保レンタル・リース
チェアパッド付黒塗装脚 価格(税抜) サイズ(mm)梱包才数梱包重量
ALES-HP-□□-□□□-B 33,900円 W505×D505×H855 (SH460)13.3才19kg 仕様/背・座:成型合板 メラミン化粧貼り フレ-ム:スチ-ル (φ15.9mm) 張地:布 入数:4 ●スタッキング不可
420 (座) 430 505 505 440 855 595 1000 スタッキング/4脚 ALES-H 420 (座) 430 505 505 460 855 ALES-HP
115 SOCIA

ALES-T
カウンターチェアとの一体感を持たせた空間を演出できます。
①は合板カラー、②はパッドカラー、末尾の「B」は黒塗装脚となります、ご注意ください。 ※注意事項 パッド付は張地の種類によって価格が異なります。 お間違えのなきようカラーをお選びください。
品番 ALES-T-□(パッド無 メッキ脚)
① ① ① ① ② ② 注意事項をご確認の上、下記のリストに従い、お好みのカラーをお選びください。
品番 ALES-T-□-B(パッド無 黒塗装脚)
品番 ALES-TP-□-□(パッド付 メッキ脚)
品番 ALES-TP-□-□-B(パッド付 黒塗装脚)


チェア 価格(税抜) サイズ(mm)梱包才数梱包重量
ALES-T-□ 25,700円 W505×D505×H675 (SH440)10.5才15kg
仕様/背・座:成型合板 メラミン化粧貼り フレ-ム:スチ-ル (φ15.9mm) 入数:4 ●スタッキング可能 (4脚まで)










①合板色 ②張地カラー
ブラウン → BR ナチュラル → NA 合成皮革(Nタイプ) ブラック → BK ブラウン → BR アイボリー → IV 合成皮革(Gタイプ) アクア → GAQ ライム → GLM イエロー → GYE

合成皮革(Cタイプ)NEW ベージュ → CBJ グリーン → CGN ブラック → CBK ネイビー → CNV ブラウン → CBR
布
ブラック → FBK グリーン → FGN ブルー → FBL マスタード → FMS ブラウン → FBR ピンク → FPK

チェア 価格(税抜) サイズ(mm)梱包才数梱包重量
ALES-T-□-B 25,700円 W505×D505×H675 (SH440)10.5才15kg 仕様/背・座:成型合板 メラミン化粧貼り フレ-ム:スチ-ル (φ15.9mm) 入数:4 ●スタッキング可能









チェア
(4脚まで)
ALES-T-NA ナチュラル
ALES-T-BR ブラウン
ALES-T-NA-B ナチュラル
ALES-T-BR-B ブラウン
SOCIA ASO-CF750B(NA) P.047
ALES-TP-NA-FGN
FMS:マスタード FGN:グリーン FBR:ブラウン FBL:ブルー FBK:ブラック FPK:ピンク CBJ:ベージュ GYE:イエロー GLM:ライム GAQ:アクア 張地(Cタイプ) 張地(Gタイプ) 合板 BR:ブラウン BK:ブラック IV:アイボリー BR:ブラウン 張地(Nタイプ) ■カラーサンプル NA:ナチュラル 発注方法の説明
※ALES-T、ALES-T-Bのみ
116

合皮(Cタイプ)
メッキ脚 塗装脚
チェアデスク・収納パーティションテーブルレセプションロビーエクステリアアクセサリー木工

ALES-TP-BR-CBK ブラウン-ブラック

ALES-TP-NA-CNV ナチュラル-ネイビー
チェアパッド付メッキ脚 価格(税抜) サイズ(mm)梱包才数梱包重量
ALES-TP-□□-□□□ 32,000円 W505×D505×H855 (SH460)13.3才19kg
仕様/背・座:成型合板 メラミン化粧貼り・背・座:成型合板 メラミン化粧貼り フレ-ム:スチ-ル (φ15.9 mm) 張地:合成皮革 入数:4 ●スタッキング不可
合皮(Nタイプ)

ALES-TP-BR-IV ブラウン-アイボリー

ALES-TP-NA-BK ナチュラル-ブラック
チェアパッド付メッキ脚 価格(税抜) サイズ(mm)梱包才数梱包重量
ALES-TP-□□-□□ 29,800円 W505×D505×H675 (SH460)11.1才17kg 仕様/背・座:成型合板 メラミン化粧貼り フレ-ム:スチ-ル (φ15.9mm) 張地:合成皮革 入数:4 ●スタッキング不可
合皮(Gタイプ)

ALES-TP-BR-CGN-B ブラウン-グリーン

ALES-TP-NA-CBJ-B ナチュラル-ベージュ
チェアパッド付黒塗装脚 価格(税抜) サイズ(mm)梱包才数梱包重量
ALES-TP-□□-□□□-B 32,000円 W505×D505×H855 (SH460)13.3才19kg 仕様/背・座:成型合板 メラミン化粧貼り フレ-ム:スチ-ル (φ15.9 mm) 張地:合成皮革 入数:4 ●スタッキング不可
塗装脚 メッキ脚 塗装脚 メッキ脚 塗装脚 メッキ脚

ALES-TP-BR-GLM ブラウン-ライム

ALES-TP-NA-GAQ-B ナチュラル-アクア
チェアパッド付メッキ脚 価格(税抜) サイズ(mm)梱包才数梱包重量
ALES-TP-□□-□□□ 36,400円 W505×D505×H675 (SH460)11.1才17kg 仕様/背・座:成型合板 メラミン化粧貼り フレ-ム:スチ-ル (φ15.9mm) 張地:合成皮革 (抗菌仕様) 入数:4 ●スタッキング不可
チェアパッド付黒塗装脚 価格(税抜) サイズ(mm)梱包才数梱包重量
ALES-TP-□□-□□□-B 36,400円 W505×D505×H675 (SH460)11.1才17kg 仕様/背・座:成型合板 メラミン化粧貼り フレ-ム:スチ-ル (φ15.9mm) 張地:合成皮革 (抗菌仕様) 入数:4 ●スタッキング不可

ALES-TP-BR-BR-B ブラウン-ブラウン

ALES-TP-NA-IV-B ナチュラル-アイボリー
チェアパッド付黒塗装脚 価格(税抜) サイズ(mm)梱包才数梱包重量
ALES-TP-□□-□□-B 29,800円 W505×D505×H675 (SH460)11.1才17kg
仕様/背・座:成型合板 メラミン化粧貼り フレ-ム:スチ-ル (φ15.9mm) 張地:合成皮革 入数:4 ●スタッキング不可
布張り

ALES-TP-NA-FBL ナチュラル-ブルー

ALES-TP-BR-FBK-B ブラウン-ブラック
チェアパッド付メッキ脚 価格(税抜) サイズ(mm)梱包才数梱包重量 ALES-TP-□□-□□□ 33,900円 W505×D505×H675 (SH460)11.1才17kg 仕様/背・座:成型合板 メラミン化粧貼り フレ-ム:スチ-ル (φ15.9mm) 張地:布 入数:4 ●スタッキング不可
幼保レンタル・リース
チェアパッド付黒塗装脚 価格(税抜) サイズ(mm)梱包才数梱包重量
ALES-TP-□□-□□□-B 33,900円 W505×D505×H675 (SH460)11.1才17kg 仕様/背・座:成型合板 メラミン化粧貼り フレ-ム:スチ-ル (φ15.9mm) 張地:布 入数:4 ●スタッキング不可
420 (座) 430 505 505 440 675 595 820 スタッキング/4脚 420 (座) 430 505 505 460 675
ALES-T ALES-TP
117 SOCIA
カウンターチェア

ALES-CT/-CTB
座下には幅360mm、高さ650mmの有効寸法があり、 収納スペースとして活用できます。
メッキ脚 塗装脚


カウンターチェア 価格(税抜) サイズ(mm)梱包才数梱包重量 ALES-CT 38,000円 W505×D520×H955 (SH715)12.0才15kg 仕様/背・座:成型合板 メラミン化粧貼り フレ-ム:スチ-ル (φ15.9mm) クロ-ムメッキ 入数:2 ●スタッキング可能 (2脚まで)




カウンターチェア 価格(税抜) サイズ(mm)梱包才数梱包重量 ALES-CTB 38,000円 W505×D520×H955 (SH715)12.0才15kg 仕様/背・座:成型合板 メラミン化粧貼り フレ-ム:スチ-ル (φ15.9mm) 粉体塗装 (ブラック) 入数:2 ●スタッキング可能 (2脚まで)

430 520 280 955 555 1005 715 420 (座) 505 スタッキング/2脚
SOCIA ASO-S9060B(BR) P.065
SOCIA ASO-WH1811B(MAK) P.043
ALES-CTB(BR)
■カラーサンプル 合板
座下には荷物を入れるための収納スペースがあります。 BR:ブラウン
ALES-CT/CTB
NA:ナチュラル
ALES-CTB(BR)
ALES-CTB(NA)
ALES-CT(BR)
118
ALES-CT(NA)
カウンターチェア
チェアデスク・収納パーティションテーブルレセプションロビーエクステリアアクセサリー木工

ASO-CTB




ASO-HC320



■カラーサンプル

BL:ブルー BR:ブラウン



LGN:ライトグリーン PK:ピンク ※製法の特性上、繊維の流れる方向により、色が異なって見えることがあります。

カウンターチェア 価格(税抜)サイズ(mm)梱包才数梱包重量
ASO-CTB 41,000円 W505×D520×H7756.1才12.7kg
仕様/張地:布 フレ-ム:スチ-ル (φ15.9mm) 粉体塗装 (ブラック) 入数:2 ●スタッキング不可
■カラーサンプル



BK:ブラック BR:ブラウン GN:グリーン



GR:グレー WIN:ワイン NA:ナチュラル

ASO-HC320W ナチュラル
400
320
フットレスト

フットレストは、錆びにくいステンレスと すべりにくいPVCを採用しています。
345
幼保レンタル・リース
280 720
ASO-HC320C ASO-HC320W
ハイチェア 価格(税抜)サイズ(mm)梱包才数梱包重量
ASO-HC320C 38,000円 W400×D345×H7154.8才11.5kg
ASO-HC320W 24,000円 W400×D345×H6904.5才12kg
仕様/座:(C)合成皮革・(W)天然木 フレ-ム:スチ-ル (φ15.9mm) 入数:2 ●スタッキング不可
380 520 280 775 400 505
345 280 690 320 400
ASO-CTB(BL) ブルー
ASO-CTB(BR) ブラウン
ASO-CTB(LGN) ライトグリーン
ASO-CTB(PK) ピンク
ASO-CTB
ASO-HC320C(GN) グリーン
グレー
ASO-HC320C(GR)
ブラウン
ASO-HC320C(BR)
ASO-CTB(LGN)
ASO-CTB(BL)
ASO-WH1811B(MAK)
ASO-HC320C(WN)
119 SOCIA
ASO-HC320C(GR)
ミーティングチェア

SC-20
テーブル CFL-T80(IV) P.235





ミーティングチェア 価格(税抜) サイズ(mm) 梱包才数梱包重量
SC-20 15,400円 W440×D450×H775 (SH440)6.5才13kg 仕様/背・座:樹脂成型品 フレ-ム:スチ-ル (φ19.1mm) クロ-ムメッキ 入数:4 ●スタッキング可能 (3脚まで)





440 775 450 881 530 440 Φ390 (座) 395 スタッキング/3脚
SC-20-GN-WH
SC-20
SC-20-GN-WH
SC-20-WH-WH
SC-20-OR-OR
SC-20-RD-RD
■カラーサンプル OR:オレンジ WH:ホワイト RD:レッド GN:グリーン NV:ネイビー 120
SC-20-NV-NV
チェア
チェアデスク・収納パーティションテーブルレセプションロビーエクステリアアクセサリー木工

EA-CH
ひらりと舞う花びらをモチーフにしたオーガニックなフォルム。
カラーを織り交ぜてコーディネートをしてもマッチします。




■カラーサンプル





幼保レンタル・リース
樹脂チェア 価格(税抜) サイズ(mm)梱包才数梱包重量
EA-CH 35,500円 W500×D605×H790(SH460)11.7才13kg 仕様/シェル:ポリプロピレン 脚:スチール(ブラック塗装) 入数:3 ●スタッキング可能(6脚まで)
460 790 605 925 500 スタッキング/ 4脚 455 520
EA-CH(BJ) EA-CH(YE)
スタッキング
BK:ブラック BJ:ベージュ PK:ピンク YE:イエロー EA-CH(PK) EA-CH(BK)
EA-CH
EA-CH(YE)
EA-CH(PK) EA-CH(BJ)
121 SOCIA
リフレッシュチェア

JCH
ブラック



樹脂チェア 価格(税抜) サイズ(mm) 梱包才数梱包重量
JCH-470B 35,000円 W470×D508×H755 (SH425)11.9才 24kg
仕様/背・座:PP樹脂成型品 張地:合成皮革 (PVC) 座裏カバ-:PP再生樹脂 フレ-ム:スチ-ル (φ15.9mm) 粉体塗装 (ブ ラック) 入数:4 ●スタッキング可能 (4脚まで) ●座裏にはスタッキング時に座面が傷つかないようPP再生樹脂が付いています。
ホワイト



樹脂チェア 価格(税抜) サイズ(mm) 梱包才数梱包重量
JCH-470W 35,000円 W470×D508×H755 (SH425)11.9才 24kg 仕様/背・座:PP樹脂成型品 張地:合成皮革 (PVC) 座裏カバ-:PP再生樹脂 フレ-ム:スチ-ル (φ15.9mm) クロ-ムメッ キ 入数:4 ●スタッキング可能 (4脚まで) ●座裏にはスタッキング時に座面が傷つかないようPP再生樹脂が付いています。
■カラーサンプル







425 755 622 935 スタッキング/4脚
430 470 508
400
JCH-470W(LGN)
JCH-470B(BK) ブラック
JCH-470B(LGN) ライトグリーン
JCH-470B(IV) アイボリー
JCH-470W(IV) アイボリー
JCH-470W(LGN) ライトグリーン
JCH-470W(BK) ブラック
背樹脂(ブラック)
座裏樹脂カバー
スタッキング例 JCH-470B/JCH-470W
背樹脂(ホワイト)
IV:アイボリ- BK:ブラック
122
LGN:ライトグリーン

TCH







チェア 価格(税抜) サイズ(mm)梱包才数梱包重量
TCH-B 18,000円 W440×D505×H730 (SH420)8.9才23kg
TCH-W 18,000円 W440×D505×H730 (SH420)8.9才23kg 仕様/背:PP樹脂成型品 張地:合成皮革 (PVC) 座裏カバ-:PP再生樹脂 フレ-ム:スチ-ル (φ 19.1mm) クロ-ムメッキ 入数:4 ●スタッキング可能 (4脚まで) ●座裏にはスタッキング時に座面が傷つか ないようPP再生樹脂が付いています。
キャスタータイプ








チェア (キャスター付) 価格(税抜) サイズ(mm)梱包才数梱包重量
TCH-BC 21,000円 W440×D505×H735 (SH425)10.4才23.5kg
TCH-WC 21,000円 W440×D505×H735 (SH425)10.4才23.5kg 仕様/背:PP樹脂成型品 張地:合成皮革 (PVC) 座裏カバ-:PP再生樹脂 フレ-ム:スチ-ル (φ19.1mm) クロ-ムメッキ 入数:4 ●スタッキング可能 (4脚まで) ●座裏にはスタッキング時に座面が傷 つかないようPP再生樹脂が付いています。

420 730 610 870 スタッキング/4脚 400 (背) 440 435 410 (座) 505 425 735 610 875 スタッキング/4脚 400 (背) 440 435 410 (座) 505
TCH-W(LGN)
TCH-B(BK) テーブル BA-3KV(WH) P.211
TCH-BC/TCH-WC
スタッキング例
TCH-B/TCH-W
スタッキング例
TCH-B(BK) ブラック
TCH-WC(IV) アイボリー
TCH-W(LGN) ライトグリーン
TCH-BC(LGN) ライトグリーン
■カラーサンプル
WH:ホワイト 背
IV:アイボリー 座 BK:ブラック 背
BK:ブラック 座 LGN:ライトグリーン 座
■カラーサンプル
WH:ホワイト 背
123 SOCIA
IV:アイボリー 座 BK:ブラック 背 BK:ブラック 座 LGN:ライトグリーン 座
チェアデスク・収納パーティションテーブルレセプションロビーエクステリアアクセサリー木工
幼保レンタル・リース


2014年8月納入 平和記念式典(広島市)
全天候型アルミ折りたたみチェア。
AFC-2A/AFC-2APU

AFC-2A(GR)


ポリウレタン樹脂製のやわらかい クッションパット付き。

背面仕様
アルミ折畳みイス 価格(税抜) サイズ(mm) 梱包才数梱包重量
AFC-2A 17,300円 W505×D450×H775 (SH440)4.0才15.5kg 仕様/背・座:樹脂成型品 フレ-ム:アルミ (φ22mm) アルマイト仕上げ 入数:6 ●フラットスタッキング可能 ●屋外対応可能
取付け金具は全 てステンレス製 の金具を使用し ているため錆び に強い設計
水抜き穴のため 雨水も座にたま りません

クッションパットは2重成型によって 内部に水が浸入しません。


スタッキング例 すっきりと収納できて スペースをとりません。
アルミ折畳みイス (クッションパット付) 価格(税抜) サイズ(mm) 梱包才数梱包重量
AFC-2APU 22,500円 W505×D450×H775 (SH415)4.0才17kg 仕様/背・座:樹脂成型品 クッション:ポリウレタン樹脂成型品 フレ-ム:アルミ (φ22mm) アルマイト仕上げ 入数:6 ●フラットスタッキング可能 ●屋外対応可能
382 392 (座) 505 450 913 775 400 30102102 折り畳み/スタッキング 382 392 (座) 505 450 775 415 913 30102102 折り畳み/スタッキング
AFC-2A
AFC-2APU
AFC-2APU(GR)
124


チェアデスク・収納パーティションテーブルレセプションロビーエクステリアアクセサリー木工



折り畳み機構
折り畳みの際の指はさみ防止 の為、折り畳み機構には安全な シリンダー方式を採用。
■カラーサンプル


折畳みイス 価格(税抜) サイズ(mm) 梱包才数梱包重量
SFC-2M 10,700円 W450×D470×H765 (SH440)3.7才20kg
仕様/張地:合成皮革 (ポリウレタンレザ-) フレ-ム:スチ-ルパイプ (φ22.2mm) クロ-ムメッキ
入数:4 ●シリンダ-式折畳み機構
折畳みイス 価格(税抜) サイズ(mm) 梱包才数梱包重量
SFC-2T 8,100円 W450×D470×H765 (SH440)3.7才20kg
仕様/張地:合成皮革 (ポリウレタンレザ-) フレ-ム:スチ-ルパイプ (φ22.2mm) 粉体塗装 (シルバ-) 入数:4 ●シリンダ-式折畳み機構
折りたたみイス FP-930

チェア台車

スタッキング例


折り畳み機構 折り畳みの際の指はさみ防止 の為、折り畳み機構には安全な シリンダー方式を採用。
折畳みイス 価格(税抜) サイズ(mm) 梱包才数梱包重量
FP-930 12,000円 W480×D510×H770 (SH425)4.1才21.2kg 仕様/背・座:樹脂成型品 フレ-ム:スチ-ル 粉体塗装 入数:5 ●フラットスタッキング可能 ●シリンダ-式折畳み機構


チェア台車 価格(税抜) サイズ(mm)梱包才数梱包重量
CRT-36S 273,000円 W980×D800×H1735 ▲ 12.1才 ▲ 40kg 仕様/フレ-ム:スチ-ル 粉体塗装 (グレ-) 入数:1 ●パイプ (φ22.2mm)の折畳みチェアの場合、最大 積載数 約30台積載可能 ●パイプ (φ19.1mm) の折畳みチェアの場合、最大積載数 約36台積載可能

チェア台車 価格(税抜) サイズ(mm)梱包才数梱包重量 KCD-L27 93,000円 W625×D1340×H8154.2才25kg 仕様/フレ-ム:スチ-ル 粉体塗装 床板:スチ-ル 粉体塗装 入数:1 ●パイプ (φ22.2mm)の折畳みチェ アの場合、最大積載数 約27台積載可能 ●パイプ (φ19.1mm) の折畳みチェアの場合、最大積載数 約30 台積載可能
幼保レンタル・リース
チェア台車 価格(税抜) サイズ(mm) 梱包才数梱包重量 KCD-T30 107,000円 W580×D1000×H159010.7才22kg 仕様/フレ-ム:スチ-ル 粉体塗装 入数:1 ●パイプ (φ22.2mm)の折畳みチェアの場合、最大積載数 約 30台積載可能 ●パイプ (φ19.1mm) の折畳みチェアの場合、最大積載数 約34台積載可能
■折り畳みチェア台車対応一覧 ※チェアの積載脚数は寸法から計測した理論値です。実際に台車に積載する場合、一台当たりの寸法は凸部と凹部が重なり合いますので、表記の台数より多く掲載できる可能性がございますので、ご注意ください。
21 440 390 (座) 480 510 935 770 415 311112 折り畳み/スタッキング 405 390 (座) 450 470 930 765 440 579090 折り畳み/スタッキング
FP-930(BK)
SFC-2M/2T
FP-930
SFC-2T 連結
品番 価格 外寸法 有効内寸 折り畳みチェア積載脚数 AFC-2AAFC-2APUSFC-2TSFC-2MFP-930 CRT-36S ¥248,000 W980×D800×H1735mm 上段:W900×D800×H600mm 下段:W900×D800×H570mm 42脚 42脚 30脚 30脚 36脚 KCD-L27 ¥93,000 W625×D1340×H815mm W550×D1200mm 27脚 27脚 27脚 27脚 27脚 KCD-T30 ¥107,000 W580×D1000×H1590mm 上段:W510×D955×H615mm 下段:W510×D955×H622mm 30脚 30脚 27脚 27脚 30脚
BR:ブラウン BL:ブルー
CRT-36S
KCD-T30
SFC-2M(BL)
KCD-L27
125 SOCIA
SFC-2T(BR)
木製チェア

MC-620




木製チェア 価格(税抜) サイズ(mm) 梱包才数梱包重量
MC-620BR 32,000円 W510×D560×H775 (SH410)4.7才16kg
MC-620NA 32,000円 W510×D560×H775 (SH410)4.7才16kg
仕様/張地:合成皮革 (ポリ塩化ビニ-ル) 座:モールドウレタン+ウェービングテープ+MDF フレ-ム:成型合板 粉体塗装 入数:2 ●スタッキング可能 (4脚まで)







張地機能に特化した木製チェア。



座った状態で椅子を引きずらないで下さい。ボルトが緩む恐れがあります。
●コンパクト設計

ワイド寸法を510㎜に抑えることで身体が収まり やすくホールド感も向上しています。
●内部構造


DC(合板構造)MC(ウェービングテープ構造)
MCは通常の合板構造とは異なり、ウェービング テープを使用しております。ウェービングテープ を使用することでクッション性に優れた座り心地 を実現しています。
※別張、完成品出荷対応可能。お気軽にお問い 合わせください。
※別張対応の場合、低ホルム仕様にはなりません。
体圧分散するクッションで 快適な座り心地のチェア
座面クッションは適度な固さのあるモール ドウレタンを採用することにより、着座時 の安定性が向上して体圧分散と姿勢保 持を両立しています。
MC-620NA/MC-620BR
※完成品出荷対応可能。お気軽にお問い合わせください。
775 560 1070 680 510 446 (座) 455 410 610 スタッキング/4脚 510
体圧分散
MC-620NA(GN)
SOCIA ASO-CF7575W(NA) P.047
MC-620NA(BJ)
MC-620BR(BJ)
MC-620BR(PK)
MC-620BR(OR)
MC-620NA(GN)
MC-620NA(OR)
■カラーサンプル
BL:ブルー GN:グリーン
PK:ピンク
IV:アイボリー BJ:ベージュ
OR:オレンジ LGN:ライトグリーン
126



豊富なカラーバリエーションで シーンに合ったお好みの色をチョイスできる木製チェア。





木製チェア 価格(税抜) サイズ(mm) 梱包才数梱包重量
MC-840BR 30,000円 W510×D560×H775 (SH410)4.7才 16kg
MC-840NA 30,000円 W510×D560×H775 (SH410)4.7才 16kg 仕様/張地:合成皮革 (ポリ塩化ビニ-ル) 座:モールドウレタン+ウェービングテープ+MDF フレ-ム:成型合板 粉体塗装 入数:2 ●スタッキング可能 (4脚まで)
■カラーサンプル







●コンパクト設計

ワイド寸法を510㎜に抑えることで身体が収まり やすくホールド感も向上しています。
●内部構造































DC(合板構造)MC(ウェービングテープ構造)
MCは通常の合板構造とは異なり、ウェービング テープを使用しております。ウェービングテープ を使用することでクッション性に優れた座り心地 を実現しています。
※別張、完成品出荷対応可能。お気軽にお問い 合わせください。
※別張対応の場合、低ホルム仕様にはなりません。
体圧分散するクッションで 快適な座り心地のチェア
座面クッションは適度な固さのあるモール ドウレタンを採用することにより、着座時 の安定性が向上して体圧分散と姿勢保 持を両立しています。
MC-840NA/MC-840BR
※完成品出荷対応可能。お気軽にお問い合わせください。
510 775 560 1070 680 510 446 (座) 455 41 0 61 0 スタッキング/ 4脚
MC-840
MC-840NA(MD17)
MC-840NA(MD77)
MC-840BR(MD79)
MC-840BR(MD90)
MC-840NA(MD80)
MC-840BR(MD80)
MC-840NA(MD84)
MD25 MD24 MD17 MD08 MD48 MD42 MD40 MD26 MD69 MD68 MD67 MD62 MD73 MD72 MD71 MD70 MD77 MD76 MD75 MD74 MD81 MD80 MD79 MD78 MD85 MD84 MD83 MD82 MD89 MD88 MD87 MD86 MD91 MD90
MC-840BR(MD48)
体圧分散 座った状態で椅子を引きずらないで下さい。ボルトが緩む恐れがあります。 127 SOCIA
チェアデスク・収納パーティションテーブルレセプションロビーエクステリアアクセサリー木工 幼保レンタル・リース
木製チェア

MC-510




コンパクト設計で座り心地の良い 低ホルム仕様の木製チェア。


●コンパクト設計

ワイド寸法を510㎜に抑えることで身体が収まり やすくホールド感も向上しています。
●内部構造


DC(合板構造)MC(ウェービングテープ構造) 木製チェア 価格(税抜) サイズ(mm) 梱包才数 梱包重量
MC-510NA 26,000円 W510×D560×H775 (SH410) 4.7才 16kg
仕様/張地:合成皮革 (ポリ塩化ビニ-ル) 座:モ-ルドウレタン+ウェ-ビングテ-プ フレ-ム:成型合板 粉体塗装 入数:2 ●スタッキング可能 (4脚まで)







木製チェア 価格(税抜) サイズ(mm) 梱包才数梱包重量 MC-510BR 26,000円 W510×D560×H775 (SH410)4.7才16kg 仕様/張地:合成皮革 (ポリ塩化ビニ-ル) 座:モ-ルドウレタン+ウェ-ビングテ-プ フレ-ム:成型合板
入数:2 ●スタッキング可能 (4脚まで)

MCは通常の合板構造とは異なり、ウェービング テープを使用しております。ウェービングテープ を使用することでクッション性に優れた座り心地 を実現しています。
※別張、完成品出荷対応可能。お気軽にお問い 合わせください。
※別張対応の場合、低ホルム仕様にはなりません。
体圧分散するクッションで 快適な座り心地のチェア
座面クッションは適度な固さのあるモール ドウレタンを採用することにより、着座時 の安定性が向上して体圧分散と姿勢保 持を両立しています。

座った状態で椅子を引きずらないで下さい。ボルトが緩む恐れがあります。
775 560 1070 680 510 446 (座) 455 410 610 スタッキング/4脚 510
粉体塗装
福祉
VMRT-K1890(WT) P.336
MC-510BR(BJ)
福祉
VFTR-1890(NA) P.338
MC-620NA(BJ)
MC-510NA(GN)
MC-510NA(BJ)
MC-510NA(OR)
MC-510NA(PK)
MC-510BR(BJ) スタッキング
スタッキング
■カラーサンプル
MC-510NA/MC-510BR
■カラーサンプル
GN:グリーン OR:オレンジ
BJ:ベージュ
PK:ピンク
BJ:ベージュ
体圧分散
128

チェアデスク・収納パーティションテーブルレセプションロビーエクステリアアクセサリー木工

DC-530P




ダイニングチェア (肘付) 価格(税抜) サイズ(mm) 梱包才数梱包重量
DC-530P 27,000円 W535×D580×H770 (SH415)4.9才17kg 仕様/張地:合成皮革 (ポリ塩化ビニ-ル) フレ-ム:成型合板 粉体塗装 入数:2 ●スタッキング可能 (4脚まで)
■カラーサンプル






座った状態で椅子を引きずらないで下さい。ボルトが緩む恐れがあります。


幼保レンタル・リース

スタッキング例
別張り・完成品出荷承ります。
DC-530P、DC-730Pは指定の張地による別張対応 が可能です。また、通常組立商品として出荷してお りますが、希望に合わせて工場出荷時に組み立て を行う完成品出荷対応が可能です。お気軽にお問 い合わせ下さい。 ※�別張り、完成品出荷につきましては別途お見積も り致します。
480 470 (座) 770 415 610 535 580 1110 760 スタッキング/4脚
DC-530P
DC-530(BJ)
DC-530P(OR)
DC-530P(PK)
DC-530P(WH)
DC-530P(BL)
DC-530P(GN)
福祉 VMRT-1890(NA) P.336
DC-530P(BL)
OR:オレンジ GN:グリーン PK:ピンク BJ:ベージュ WH:ホワイト
BL:ブルー
129 SOCIA
木製チェア
DC-730P
座った状態で椅子を引きずらないで下さい。ボルトが緩む恐れがあります。

ダイニングチェア (肘付) 価格(税抜)

サイズ(mm) 梱包才数梱包重量
DC-730P 27,000円 W535×D580×H770 (SH415)4.9才 17kg
仕様/張地:合成皮革 (ポリ塩化ビニ-ル) フレ-ム:成型合板 粉体塗装 入数:2 ●スタッキング可能 (4脚まで)
DC-430P
■カラーサンプル






ダイニングチェア (肘なし) 価格(税抜) サイズ(mm) 梱包才数梱包重量
DC-430P 27,000円 W535×D580×H770 (SH415)4.9才 17kg
仕様/張地:合成皮革 (ポリ塩化ビニ-ル) フレ-ム:成型合板 粉体塗装 入数:2 ●スタッキング可能 (4脚まで)
FC-570P


折畳みチェア 価格(税抜) サイズ(mm)梱包才数梱包重量
FC-570P 29,000円 W475×D590×H800 (SH415)2.2才7kg
仕様/張地:合成皮革 (ポリ塩化ビニ-ル) フレ-ム:成型合板 粉体塗装 入数:1
■カラーサンプル




カラーサンプルについては「福祉」の P.348をご参照ください。


480 470 (座) 770 415 610 535 580 1110 760 スタッキング/4脚 480 470 (座) 770 415 535 580 1110 760 スタッキング/4脚 908 400 410 (座) 800 415 475 590 122 145 折り畳み/スタッキング
BK:ブラック BJ:ベージュ
BL:ブルー GN:グリーン BJ:ベージュ 折畳み時
FC-570P
DC-430P
DC-730P
DC-730P(BJ)
DC-730P(BK)
DC-430P(BL)
DC-430P(BJ)
DC-430P(GN)
FC-570P(MD08)
FC-570P(MD79)
FC-570P(MD85)
130
チェアデスク・収納パーティションテーブルレセプションロビーエクステリアアクセサリー木工

SFS-430(BR)
SFS-430

ASO-W1111W(WH)
SFS-430(GR)
長時間座ってもムレない使い勝手の良い角スツール。

スタッキングスツール 価格(税抜) サイズ(mm) 梱包才数梱包重量
SFS-430F 16,000円 W500×D470×H430 (SH420)6.0才 17.4kg
仕様/張地:布 脚:スチ-ル 粉体塗装(ブラック) 入数:5 ●スタッキング可能(5脚まで)

横に複数台並べた際、きれいに並べることが出来るよう、 標準で連結プラパートが取り付けられています。


強度と通気性を兼ね備えたハニカム構造の座裏樹脂。
幼保レンタル・リース
■カラーサンプル


DBL:ダークブルー GR:グレー BR:ブラウン


38 500 430 20 420 (座) 470 470 430 420 スタッキング/ 5脚 420 (座) 582 550
スツール
SFS-430(BR)
SFS-430(DBL)
SFS-430(GR)
SFS-430
スタッキング
WBC-9045B
131 SOCIA
スツール
TMO


背付チェア (キャスターなし)/ (キャスター付)




座裏にはスタッキング時に座面を傷付けな い樹脂カバーが付いています。
価格(税抜) サイズ(mm)
TMO-S 19,200円 W410×D465×H640(SH460)6.5才10kg
TMO-SC 21,800円 W410×D465×H640(SH460)6.5才11kg 仕様/張地:合成皮革張り(PVC) 座裏カバー:ポリプロピレン 脚:スチール(Φ22.2) 粉体塗装(ダークグレー) キャスター(TMO-SCのみ):ナイロンキャスター(Φ50mm双輪) 入数:2 ●TMO-SCのみキャスター(ストッパー無4個付) ●スタッキング可能(6脚まで)

TSN-ST
個付) ●スタッキング可能(6脚まで)



スツール 価格(税抜) サイズ(mm) 梱包才数梱包重量
TSN-ST 14,100円 W353×D353×H4654才13kg
仕様/張地:布張り(アクリル70% ウール30%) 座裏カバー:ポリプロピレン 脚:スチール(Φ22.2mm) 粉体塗装(サテンブラック) 入数:4 ●スタッキング可能(6脚まで)







座フレームはマット感のあるサテン塗装を施し てあります。


ボリュームのある座 (座の総厚み60mm)
335 335 Φ350 465 90 465 スタッキング
スタッキング
スタッキング
BR:ブラウン
座裏樹脂
GN:グリーン
IV:アイボリー DBR:ダークブラウン
BL:ブルー BJ:ベージュ
TMO-S(DBR)
TMO-SC(LGN)
TMO-SC(MS)
TMO-NC(DBR)
TMO-NC(MS)
TMO-S/TMO-SC
TSN-ST(BR) TSN-ST
TSN-ST(BL)
TSN-ST(BE)
TSN-ST(GN)
TMO-N/TMO-NC
TMO-N(LGN)
TSN-ST(GN)
TSN-ST(BR)
TSN-ST(BJ)
132
TSN-ST(BL)
スツール HM-320
チェアデスク・収納パーティションテーブルレセプションロビーエクステリアアクセサリー木工

ST-32TN

ポイント
・強度、耐久性を重視したパイプ肉厚t1.2mm。
・生地裏打ち有り。摩耗に強い。
ドーナツイス


スタッキング例

座裏に樹脂カバーがついており、スタッキングの際 に下のイスを傷付けない仕様になっています。
木座スツール 価格(税抜)サイズ(mm)梱包才数梱包重量
HM-320 11,000円 W320×D320×H4502.9才 14kg
仕様/座板:(t21mm) 塗装 (ナチュラル) 座裏カバ-:再生PP (グレ-) フレ-ム:スチ-ル (φ19.1mm) 粉体塗装 (メタリッ クシルバ-) 入数:6 ●スタッキング可能 (6脚まで) ●座裏にはスタッキング時に座面が傷つかないようPP再生樹脂が付い ています。

スツール 価格(税抜)サイズ(mm)梱包才数梱包重量
ST-32TN 6,000円 W320×D320×H4604.0才 20kg
仕様/張地:合成皮革 (ポリウレタンレザー) 脚:スチール (φ22.2mm) 粉体塗装 (シルバー) 入数:10
●スタッキング可能10脚まで




■カラーサンプル ■カラーサンプル






ドーナツイス 価格(税抜)サイズ(mm)梱包才数梱包重量
ドーナツイス 5,000円 φ320×H420 3.6才 17kg
仕様/張地:合成皮革 脚:スチ-ル (φ19.1mm) メラミン焼付塗装 入数:10 ●スタッキング可能 (5脚まで)




幼保レンタル・リース

丸イス 価格(税抜)サイズ(mm)梱包才数梱包重量
丸イス 4,600円 φ320×H420 3.6才 16kg
仕様/張地:合成皮革 脚:スチ-ル (φ19.1mm) メラミン焼付塗装 入数:10 ●スタッキング可能 (5脚まで)
丸イス
ライトブルー ライトブルー レッド レッド ライトグリーン ライトグリーン ブラック ブラック
HM-320
ST-32TN(BK)
ドーナツイス(ブラック)
丸イス(ブラック)
丸イス(ライトブルー)
丸イス(ライトグリーン)
丸イス(レッド)
ドーナツイス(ライトブルー) ドーナツイス(ライトグリーン) ドーナツイス(レッド)
133 SOCIA
ST-32TN(BL)
昇降デスク

天板昇降は、ガスシリンダー式を採用し、電源を必要としないため レイアウトも自由自在。キャスターが脚部後方に設置されており、 デスク手前を持ち上げると簡単に移動ができます。
 LDC-L127B(NA)
G-TN18
LDC-TP1270(BL)
SKC-1(BK)
CK02(OR)
LDC-L127B(NA)
LDC-L127W(WH)
LDC-TP1270(BL)
LDC-L127W(WH)
LDC-L127B(NA)
G-TN18
LDC-TP1270(BL)
SKC-1(BK)
CK02(OR)
LDC-L127B(NA)
LDC-L127W(WH)
LDC-TP1270(BL)
LDC-L127W(WH)
134
テーブル
レセプション
ロビー
エクステリア
アクセサリー
レンタル・リース
SKC-01(OL)
Desk / Storage Partition
Table
Reception
Lobby
Exterior
Accessories Woodworking Welfare
チェアデスク・収納パーティションテーブルレセプションロビーエクステリアアクセサリー木工



昇降デスク 価格(税抜) サイズ(mm) 梱包才数梱包重量
LDC-L127W 122,000円 W1200×D700×H720~11456.2才 38.8kg
仕様/天板:パ-ティクルボ-ド (t27mm) メラミン化粧板 フレ-ム:スチ-ル 粉体塗装 入数:1(2個口) ●天板昇降 (ガスシリンダ-式) 機能付 ●キャスタ-:ストッパ-無2個付 ●静止平均荷重:30kg


昇降デスク 価格(税抜) サイズ(mm) 梱包才数梱包重量
LDC-L127B 122,000円 W1200×D700×H720~11456.2才 38.8kg
仕様/天板:パ-ティクルボ-ド (t27mm) メラミン化粧板 フレ-ム:スチ-ル 粉体塗装 入数:1(2個口)
●天板昇降 (ガスシリンダ-式) 機能付 ●キャスタ-:ストッパ-無2個付 ●静止平均荷重:30kg


上下昇降
天板の高さを調節することができま す。仕事内容や体調に合わせた作 業環境が作れます。

昇降レバー
レバーを握ることで天板高を無段階で 昇降させることが可能です。
昇降調整 天板高調調整のために、脚に 50mmピッチで目盛りが設けてあり ます。

キャスター




BK:ブラック
■カラーサンプル フレーム 天板


WH:ホワイト

DBR:ダークブラウン NA:ナチュラル WH:ホワイト

天板に追従して昇降します。姿勢が変わっても、周囲からの視線を遮り続けます。
昇降用デスクトップパネル 昇降デスクW1200<ガスシリンダー式>H720mm~1145mm

幼保レンタル・リース
机上面H330 手元はしっかり隠しつつも、顔を上げれば対面のワーカーとのコミュニケーションが可能です。
トップパネル 価格(税抜)サイズ(mm)梱包才数梱包重量 LDC-TP1270 29,000円 W1200×D25×H7002.0才 8kg 仕様/パネル:ペ-パ-ハニカム 表面布張り フレ-ム:アルミ押出成型品 アルマイト仕上げ 入数:1 ●取付可能な天 板厚 (13~34mm) ●パネル取り付け後、天板上からパネル上までH330mmになります。 LDC-L
LDC-L127W(WH)
LDC-L127W(NA)
LDC-L127W(BR)
LDC-L127B(WH)
LDC-L127B(NA)
LDC-L127B(BR)
LDC-TP1270(BL)
取付け可能デスク 13mm~34mm厚の天板に 取り付け可能です。
LDC-TP1270(GR)
40mm 40mm 25mm 40mm 13 34mm 40mm 40mm 25mm 40mm 13 34mm 135 SOCIA
LDC-B90(WH)
LDC-K127-R3(WH)

チェア CK01(GN) P.079
LDCデスク
片袖机
オフィスのイメージに合わせて、 サイズや天板カラーが選べます。

引出し内寸 上段/W318×D421×H59(98)mm 中段/W318×D421×H144(187)mm 下段/W318×D487×H185(286)mm
片袖机 価格(税抜)サイズ(mm)梱包才数梱包重量
LDC-K107-R3 79,000円 W1000×D700×H70010.4才46.6kg
LDC-K127-R3 81,000円 W1200×D700×H70010.9才51kg
仕様/天板:パ-ティクルボ-ド (t27mm) メラミン化粧板 (ナチュラル)・天板:パ-ティクルボ-ド (t27mm) メラ ミン化粧板 (ホワイト) 脚フレ-ム:スチ-ル 粉体塗装 (ホワイト) 幕板:スチ-ル 粉体塗装 (ホワイト) 袖箱: スチ-ル 粉体塗装 (ホワイト) 入数:1(3個口) ●仕切板:中サイズ1枚、大サイズ1枚 ●ペントレ-:1個付

センター引き出し A3用紙がそのまま入るワイドな引き出し。 ※�LDC-H107、LDC-R167はA3用紙非対応ですので、 ご注意ください。

LDC-H90R(WH)
LDC-H90S(WH)
LDC-K127-R2(NA)
引出し内寸 上・下段/W318×D487×H185(286)mm

WH:ホワイト NA:ナチュラル ■カラーサンプル 天板


片袖机 価格(税抜)サイズ(mm)梱包才数梱包重量 LDC-K107-R2 79,000円 W1000×D700×H70010.4才46kg LDC-K127-R2 81,000円 W1200×D700×H70010.9才50.4kg 仕様/天板:パ-ティクルボ-ド (t27mm) メラミン化粧板 (ナチュラル)・天板:パ-ティクルボ-ド (t27mm) メラ ミン化粧板 (ホワイト) 脚フレ-ム:スチ-ル 粉体塗装 (ホワイト) 幕板:スチ-ル 粉体塗装 (ホワイト) 袖箱: スチ-ル 粉体塗装 (ホワイト) 入数:1(3個口) ●仕切板:大サイズ2枚

配線ホール すべての機種のデスク天板には、開口部の広い配線 ホールが左右についています。
■配線ホール位置/デスク奥から30mm、左右120mm ■配線ホールサイズ/閉:W116×D42、開:W200×D42

ペントレー 袖箱、インワゴン3段、脇机3段の 最上段には、ペントレーが付属しています。

ダブルサスペンションレール
LDC-K、LDC-R、LDC-WD、WJ-INは ファイル収納等に便利な大型引き出し。 すべてに丈夫でスムーズに開閉するダブ ルサスペンションを採用。
630 1200/1000 100 198 700 762/562 700 630 1200/1000 100 198 700 762/562 700
LDC-K107-R3(WH)
LDC-K107-R3・K127-R3
LDC-K107-R2・K127-R2
136
チェアデスク・収納パーティションテーブルレセプションロビーエクステリアアクセサリー木工

平机 価格(税抜)サイズ(mm)梱包才数梱包重量
LDC-H107 53,000円 W1000×D700×H7004.4才30.4kg
LDC-H127 55,000円 W1200×D700×H7004.9才35.2kg
LDC-H147 65,000円 W1400×D700×H7005.4才39.5kg
仕様/天板:パ-ティクルボ-ド (t27mm) メラミン化粧板 (ナチュラル)・天板:パ-ティクルボ-ド (t27mm) メラ ミン化粧板 (ホワイト) 脚フレ-ム:スチ-ル 粉体塗装 (ホワイト) 幕板:スチ-ル 粉体塗装 (ホワイト) 入数: 1(3個口)
両袖机

引出し内寸
2段 上・下段 W318×D487×H185(286)mm
3段
上段/W318×D421×H59(98)mm 中段/W318×D421×H144(187)mm
下段/W318×D487×H185(286)mm
両袖机 価格(税抜)サイズ(mm)梱包才数梱包重量
LDC-R147-LR22 118,000円 W1400×D700×H70016.5才70.9kg
LDC-R147-LR23 118,000円 W1400×D700×H70016.5才71.6kg
LDC-R147-LR33 118,000円 W1400×D700×H70016.5才72.3kg
LDC-R167-LR22 124,000円 W1600×D700×H70017.3才76.2kg
LDC-R167-LR23 124,000円 W1600×D700×H70017.3才77kg
LDC-R167-LR33 124,000円 W1600×D700×H70017.3才77.6kg
仕様/天板:パ-ティクルボ-ド (t27mm) メラミン化粧板 (ナチュラル/ホワイト) 脚フレ-ム:スチ-ル 粉体 塗装 (ホワイト) 幕板:スチ-ル 粉体塗装 (ホワイト) 袖箱:スチ-ル 粉体塗装 (ホワイト) 入数:1(4個口) ●仕切板:(LR23)/中サイズ1枚大サイズ3枚、(LR33)/中サイズ2枚大サイズ2枚、(LR22)/大サイズ4枚 ●ペントレー:(LR23)/1個付、(LR33)/2個付


引出し内寸

上段/W318×D421×H59(107)mm
中段/W318×D421×H97(166)mm
下段/W318×D487×H155(262)mm
インワゴン 価格(税抜)サイズ(mm)梱包才数梱包重量
WJ-IN2(WH) 44,000円 W395×D550×H6156.0才24kg
WJ-IN3(WH) 44,000円 W395×D550×H6156.0才24kg
仕様/天板:スチ-ル 粉体塗装 (ホワイト) 袖箱:スチ-ル 粉体塗装 (ホワイト) 幕板:スチ-ル 粉体塗装 (ホ ワイト) 入数:1 ●仕切板:(IN2) 中サイズ2枚、(IN3) 小サイズ1枚、中サイズ1枚 ●ペントレー:WJ-IN3/1 個付
脇机

WJ-IN2(WH) WJ-IN3(WH) 引出し内寸 上・下段 W318×D487×H155(262)mm 引出し内寸 上・下段 W318×D487×H185(286)mm
WJ-IN2 WJ-IN3

LDC-WD3(WH)
LDC-WD2(NA)
引出し内寸
上段/W318×D421×H59(98)mm
中段/W318×D421×H144(187)mm
下段/W318×D487×H185(286)mm
脇机 価格(税抜)サイズ(mm)梱包才数梱包重量
LDC-WD2 53,000円 W400×D700×H7007.6才28kg
LDC-WD3 55,000円 W400×D700×H7007.6才28kg
仕様/天板:パ-ティクルボ-ド (t27mm) メラミン化粧板 (ナチュラル/ホワイト) 袖箱:スチ-ル 粉体塗装 (ホワイト) 入数:1(2個口) ●仕切板:WD2/大サイズ2枚、WD3/中サイズ1枚大サイズ1枚 ●ペントレー LDC-WD3/1個付
オプションアジャスター 価格(税抜)サイズ(mm)梱包才数梱包重量
LDC-AJ 1,300円 φ40×H350.01才0.1kg
仕様/本体:樹脂成型品 (グレ-) 入数:2(1個口) ●必要個数:平机・脇机=2セット、片袖机= 3セット、両袖机=4セット
・�オプションアジャスター(LDC-AJ)を付けることでデスクの高さを H720mm に変更することが可能です。( 新JIS対応)
LDC-WD2 LDC-WD3
オプション仕切板
TJ-OPSHIKI 17
幼保レンタル・リース
仕切板 (大) オープン
TJ-OPSHIKI S
仕切板 (中) オープン
TJ-OPSHIKI Z
仕切板 (小) オープン
630 1400/1200/1000 100 198 700 1314/1114/914 700 395 550 615 395 550 615 400 109 700 700 400 109 700 700 630 1600 109 198 700 810 700 630 1600 109 198 700 810 700 630 1600 109 198 700 810 700 630 1400 109 198 700 610 700 630 1400 109 198 700 610 700 630 1400 109 198 700 610 700
平机
インワゴン
LDC-H127(WH)
LDC-H107・H127・H147
LDC-R147-LR23(WH)
LDC-R167-LR22
LDC-R147-LR23
LDC-R147-LR33
LDC-R147-LR22
LDC-R167-LR23
LDC-R167-LR33
LDC-WD3+LDC-AJ
ポイント 137 SOCIA
デスクトップパネル
KFP
パネルはピンがささりやすいフェルト素材を採用。
高さは350mmで程よく視線を遮り、圧迫感を与えません。

■カラーサンプル


取り付け金具 パネル端から金具端まで 35mm
KAP
13mm~34mm厚の 天板に取り付け可能 です。


KFP-1200(BL)

KFP-1400(BL)
フェルトトップパネル 固定型 価格(税抜)サイズ(mm)梱包才数梱包重量
KFP-1000 20,000円 W1000×D25×H3500.9才 2.8kg
KFP-1200 21,000円 W1200×D25×H3501.0才 3kg
KFP-1400 27,000円 W1400×D25×H3501.2才 3.2kg
仕様/パネル:フェルト (ポリエステル) フレ-ム:アルミ押出成型品 アルマイト仕上げ 入数:1
●取付可能な天板厚 (13~34mm)
高さ500mmで十分な飛沫防止効果が期待できます。
透明なアクリルパネルなので空間に開放感を与えます。


KAP-1000

KAP-1200

KAP-1400
クリアトップパネル 価格(税抜)サイズ(mm)梱包才数梱包重量
KAP-1000 24,000円 W1000×D25×H5001.2才 4.2kg
KAP-1200 26,000円 W1200×D25×H5001.5才 5kg
KAP-1400 28,000円 W1400×D25×H5001.7才 5.8kg
13mm~34mm厚の
仕様/パネル:アクリル樹脂 (t3.0mm) フレ-ム:アルミ押出成型品 入数:1(1個口)
●取付可能な天板厚 (13~34mm)
35mm 手元を隠しつつ、コミュニケーションが 取りやすいH350mmパネル 飛沫の広がりを抑えつつ、視界を圧 迫しないクリアなH500mmパネル 500 mm 350 mm 25mm 40mm
34mm 25mm 40mm
34mm
13
13
KFP-1000(BL)
天板に取り付け可能 です。
BL:ブルー
138
デスクトップパネル
チェアデスク・収納パーティションテーブルレセプションロビーエクステリアアクセサリー木工
天板に追従して昇降します。姿勢が変わっても、周囲からの視線を遮り続けます。



トップパネル 価格(税抜)サイズ(mm)梱包才数梱包重量
LDC-TP1270 29,000円 W1200×D25×H7002.0才8kg
取付け可能デスク 13mm~34mm厚の天板に 取り付け可能です。
アクリルトップパネル
LDC-TP ACS

KVP

仕様/パネル:ペ-パ-ハニカム 表面布張り フレ-ム:アルミ押出成型品 アルマイト仕上げ 入数:1 ●取付可能な天板厚 (13~34mm) ●パネル取り付け後、天板上からパネル上までH330mmになります。

10mm 工具不要の簡単組立 脚の溝にはめ込むだけ。
アクリルスクリーン 価格(税抜)サイズ(mm)梱包才数梱包重量
ACS-900 32,000円 W900×D200×H8001.4才4kg
仕様/パネル:アクリル樹脂 (t1.8mm) 脚:アクリル樹脂 (t4.8mm) 入数:1

幼保レンタル・リース

飛沫防止パネル 価格(税抜)サイズ(mm)梱包才数梱包重量
KVP-60 27,000円 W660×D70×H7003.4才13.2kg
KVP-90 30,000円 W960×D70×H7005.0才17.4kg
仕様/パネル:PET透明 (t1.0mm) フレ-ム:スチ-ル (φ12.7mm) ベ-ス:スチ-ル 入数:5(1個口)
●連結可能 ●任意角度調整可能
40mm 40mm 25mm 40mm 13 34mm 40mm 40mm 25mm 40mm 13 34mm
机上面H330 手元はしっかり隠しつつも、顔を上げれば対面のワーカーとのコミュニケーションが可能です。
LDC-TP1270(BL)
ACS-900
KVP-60
KVP-90
ワンタッチ連結可能
LDC-TP1270(GR)
139 SOCIA
スチール書庫

LDC-H90R(WH)
LDC-H90S(WH)
LDC-B90(WH)
組み立て式で完成品の書庫に比べ約70%小さく梱包、運送・搬入コストが軽減できます。
スチールと樹脂部品は容易に分解、廃棄することが可能です。

LDC-H90N(WH)
スチール書庫 (オープン)
LDC-H90N(WH)
価格(税抜)サイズ(mm)梱包才数梱包重量
LDC-H90N 47,500円 W900×D400×H10504.5才27kg
仕様/本体:スチ-ル 粉体塗装 (ホワイト) 入数:1 ●連結金具付 ●可動棚2枚付 ●A4ファイル収納可

スチール書庫用
ベース
価格(税抜)サイズ(mm)梱包才数梱包重量
LDC-B90 9,700円 W900×D400×H501.1才3.8kg
仕様/本体:スチ-ル 粉体塗装 (ホワイト) 入数:1

全ての部材が分解可能
LDC書庫は組立式書庫です。した がってすべての部材が分解可能な ので廃棄する際には容易に分解し て廃棄することが可能です。また、 納品時のサイズは従来の書庫に比 べ約70%小さく出来るのでいままで の3倍以上の数量を運ぶ事が可能 です。


LDC-H90S(WH)

LDC-H90R(WH)
スチール書庫 (スチール扉) 価格(税抜)サイズ(mm)梱包才数梱包重量 LDC-H90S 70,000円 W900×D400×H10505.4才 ▲ 35kg 仕様/本体:スチ-ル 粉体塗装 (ホワイト) 扉:スチ-ル 粉体塗装 (ホワイト) 入数:1 ●連結金具付 ●可動棚2枚付 ●A4ファイル収納可 ●鍵付 (2個)
スチール書庫 (両開き扉) 価格(税抜)サイズ(mm)梱包才数梱包重量 LDC-H90R 69,000円 W900×D400×H10505.8才 ▲ 36kg 仕様/本体:スチ-ル 粉体塗装 (ホワイト) 扉:スチ-ル 粉体塗装 (ホワイト) 入数:1 ●連結金具付 ●可動棚2枚付 ●A4ファイル収納可 ●鍵付 (2個) ●ラッチ機構付
LDC-B90(WH) 施錠時
上下・横連結 上下連結、横連結ともにネジ、ナッ トにてしっかり連結可能です。(連 結用ネジセット付属)

レベル調整 設置時のレベル調整も、設置後 に本体底板の上から六角レンチ1 本で調整が可能です。

棚位置は20mm ピッチで調節 オープン、スチール扉、アクリル扉 すべて棚板二枚付き。20mmピッ チで調節が可能。


解錠時
スチール扉・オープン・両開き扉は床に直置きすると、床の水平状態によっては本体に歪みが生じる可能性がございます。 ご使用の際は、床に接する面に必ずベースを設置した上でお使い下さい。
900 400 862 314 1050 998
注意
140
スチール書庫用天板
チェアデスク・収納パーティションテーブルレセプションロビーエクステリアアクセサリー木工



サイズバリエーションの組み合わせが豊富。
幅900用天板
LDC-9040-TOP(BR)



シーンに合わせて、書庫カウンターが設置可能。


LDC-9040-TOP(MAK)

LDC-9040-TOP(NA)

LDC-9040-TOP(WH)
スチール書庫用天板 価格(税抜)サイズ(mm)梱包才数梱包重量
LDC-9040-TOP 29,000円 W900×D400×H220.5才6.5kg
仕様/天板:パ-ティクルボ-ド 抗ウイルスメラミン化粧板 (t22mm) 抗ウイルスABSエッジ 天板裏:抗ウイルス バッカ- 入数:1 ※組立は書庫の連結用ボルトを使用してください。
■天板カラーサンプル

BR:ブラウン
幅1800用天板
LDC-1840-TOP(NA)
LDC-H90N(WH)
LDC-B90(WH)

NA:ナチュラル MAK:ミディアムオーク


WH:ホワイト

LDC-1840-TOP(BR)

LDC-1840-TOP(MAK)

LDC-1840-TOP(NA)
幼保レンタル・リース

LDC-1840-TOP(WH)
スチール書庫用天板 価格(税抜)サイズ(mm)梱包才数梱包重量
LDC-1840-TOP 41,000円 W1800×D400×H220.9才12kg 仕様/天板:パ-ティクルボ-ド 抗ウイルスメラミン化粧板 (t22mm) 抗ウイルスABSエッジ 天板裏:抗ウイルス バッカ- 入数:1 ※組立は書庫の連結用ボルトを使用してください。
141 SOCIA
パーソナルロッカー
SOCIAの各ベースにフィットする個人用ロッカーです。 鍵とポストを備え、テレワーク社員の書類も管理が容易です。


■扉カラーサンプル

NA:ナチュラル

BK:ブラック ■本体カラーサンプル

WH:ホワイト










木製パーソナルロッカー 価格(税抜) サイズ(mm) 梱包才数梱包重量
仕様/天板:ポリエステル化粧板 フラッシュ加工 本体:パ-ティクルボ-ド プリント紙化粧板貼り 扉:パ-ティクルボ-ド プリント紙化粧板貼り 入数:1(2個口) ●鍵付 (各2個) ●ネ-ムプレ-ト付 ●可動棚4枚付 ●アジャスタ-付 ●背面化粧板貼り
11 10 900 416 119382 400
PRO-4W
円 W900×D400×H1110 5.3才 41kg PRO-4B 92,000円 W900×D400×H1110 5.3才 41kg
92,000
収納例2
PRO-4B(NA)(ネームプレート付)
収納例1
PRO-4W(NA)(ネームプレート付)
収納例3
鍵付
ポスト投函口
天板活用法
PRO-4
可動棚付き(30㎜ピッチ)
ポスト内部
PRO-4
PRO-4W
PRO-4B
142
チェアデスク・収納パーティションテーブルレセプションロビーエクステリアアクセサリー木工

ロッカー
















梱包才数梱包重量
PMR-3B 128,000円 W900×D500×H10606才 48kg 仕様/天板:抗ウイルスメラミン化粧板(22㎜厚) 抗ウイルスABSエッジ 天板裏:抗ウイルスバッカー 本体・扉:プリント紙化粧板貼り 脚:スチール粉体塗装 入数:1(4個口) ●鍵付(各2個) ●ネームプレート付 ●アジャスター付 ●背面化粧板貼り ●ハンガーパイプ付
1060 900 269 105 840 500 773 460 450
木製パーソナル ロッカー 価格(税抜) サイズ(mm)
PMR-3B
PMR-3B
ポスト投函口
ネームプレート
天板活用例
PMR-3B
ポスト内部
鍵付き
ハンガーパイプ
使用例1
使用例2
MAK:ミディアムオーク BK:ブラック
本体 天板
■カラーサンプル
PMR-3B
PHN-1200(MAK)
143 SOCIA
KOL-F1(BR)
幼保レンタル・リース


チェア ALES-HP-NA-FMS-B
チェア ALES-HP-BR-FBL-B
シェルフ
■SOCIAシリーズ天板カラーサンプル


600mm

シェルフ 価格(税抜)




奥行600mmと450mmのバリエーション。

BR:ブラウン

MAK:ミディアムオーク



SGR:ストーングレー NA:ナチュラル WH:ホワイト
600mmタイプはディスプレイ棚として、450mmタイプは空間を間仕切るレイアウトに最適です。



仕様/天板:抗ウイルスメラミン化粧板 (t20mm) 抗ウイルスABSエッジ(SGRは通常ABS) 天板裏:抗ウイルスバッカ- 棚板:抗ウイルスメラミン化粧板 (t17mm) 脚:スチール 粉体塗装(B・ブラック、W・ホワイト) 入数:1(3個口)
450mm




シェルフ 価格(税抜)
仕様/天板:抗ウイルスメラミン化粧板 (t20mm) 抗ウイルスABSエッジ(SGRは通常ABS) 天板裏:抗ウイルスバッカ- 棚板:抗ウイルスメラミン化粧板 (t17mm) 脚:スチール 粉体塗装(B・ブラック、W・ホワイト) 入数:1(3個口)
37 404 450 900 854 331331331 1130 37 554 600 900 854 331331331 1130
サイズ(mm) 梱包才数 梱包重量 ASO-S9045B 101,000円 W900×D450×H1130 4.0才 40.5kg ASO-S9045W 101,000円 W900×D450×H1130 4.0才 40.5kg
サイズ(mm) 梱包才数 梱包重量 ASO-S9060B 126,000円 W900×D600×H1130 5.7才 47.2kg ASO-S9060W 126,000円 W900×D600×H1130 5.7才 47.2kg
ASO-S9060W(NA)
ASO-S9045B(NA)
ASO-S9045B(WH) ASO-S9045W(SGR)
ASO-S9045W(BR)
ASO-S9060W(WH)
ASO-S9060B(MAK)
ASO-S9060B(SGR)
ASO-S9060B(NA)
ASO-S9045B(BR)
P.115
P.115
ASO-S9045
ASO-S9060
144

食器棚
チェアデスク・収納パーティションテーブルレセプションロビーエクステリアアクセサリー木工



WH:ホワイト NA:ナチュラル
SDP 扉はマグネットラッチ機構で簡単開閉。 可動棚5枚付。収納物に合わせた高さに調整可能。


食器棚 価格(税抜)サイズ(mm)梱包才数梱包重量
SDP-1800 49,000円 W600×D395×H1800
▲ 4.4才
▲ 33.6kg 仕様/パ-ティクルボ-ド プリント紙化粧板貼り 入数:1 ●可動棚5枚付

マグネットラッチ機構 扉の表面を軽く押すだけでスムーズに開 閉が可能。扉の内側にマグネットがつい ており、磁力で扉を固定します。

棚板調節
棚板は30mmピッチ で調整が可能です。

転倒防止補助 バンド 付属の樹脂バンドで食器 棚と壁面を固定でき、転 倒防止対策。

幼保レンタル・リース
565 565 350 755 1800 355 355 355 380 600 395
SDP-1800(NA)
SDP-1800
SDP-1800(NA)
SDP-1800(WH)
SDP-1800(WH)(使用例)
■カラーサンプル 145 SOCIA
ファイルワゴンシリーズ

NFW-460(WH)

NFW-660(WH)

NFW-860(WH)

NFW-463(WH) NFW-663(WH)


NFW-863(WH)
ファイルワゴン 価格(税抜)サイズ(mm)梱包才数梱包重量
NFW-460 58,000円 W473×D360×H8852.1才12.8kg
NFW-660 63,000円 W677×D360×H8852.1才15.2kg
NFW-860 76,000円 W882×D360×H8852.4才18.2kg
仕様/棚板:スチ-ル 粉体塗装 フレ-ム:スチ-ル 粉体塗装 サポ-ト:スチ-ル クロ-ムメッキ 入数:1 ●キャスタ-:φ75mm 静音キャスタ-(ストッパ-付2個、ストッパ-無2個) ●ラック有効内寸:W402/606/811 ×D225×H320mm ●サポ-ト4本付
ファイルワゴン 価格(税抜)サイズ(mm)梱包才数梱包重量
NFW-463 89,000円 W473×D360×H12902.1才12.8kg
NFW-663 103,000円 W677×D360×H12902.9才22.7kg
NFW-863 112,000円 W882×D360×H12903.4才26.9kg 仕様/棚板:スチ-ル 粉体塗装 フレ-ム:スチ-ル 粉体塗装 サポ-ト:スチ-ル クロ-ムメッキ 入数:1 (2個口) ●キャスタ-:φ75mm 静音キャスタ-(ストッパ-付2個、ストッパ-無2個) ●ラック有効内 寸:W402/606/811×D225×H320mm ●サポ-ト6本付

KFW-20
棚内寸
W550×D310×H340mm

KFW-30
棚内寸
W550×D310× H(上段)21/(下・中段)34mm
変更時
W550×D310× H(上段)275/(中段)28/ (下段)340mm

棚内寸
KFW-40
W550×D310× H(上段)365/(中・下段)340mm
ファイルワゴン 価格(税抜)サイズ(mm)梱包才数梱包重量
KFW-20 76,200円 W610×D395×H8503.1才16kg
KFW-30 86,600円 W610×D395×H10603.9才21kg
KFW-40 93,000円 W610×D395×H12104.5才22kg
仕様/棚板:スチ-ル 粉体塗装 (ライトグレ-) フレ-ム:スチ-ル (〼25mm) 粉体塗装 (ホワイトグレ-) 入数:1 ●キャスタ-:ストッパ-付2個、ストッパ-無2個


OKW-35 OKW-36
棚内寸(下段) W590×D215×H360mm
棚内寸(中段) W590×D215×H360mm
棚内寸(下段) W590×D215×H360mm
ファイルワゴン 価格(税抜)サイズ(mm)梱包才数梱包重量
OKW-35 25,000円 W630×D294×H7851.3才9kg
OKW-36 32,000円 W630×D294×H11751.9才13kg
仕様/本体:パ-ティクルボ-ド プリント化粧板貼り 入数:1
146
アンダーデスクワゴン
チェアデスク・収納パーティションテーブルレセプションロビーエクステリアアクセサリー木工


アンダーデスクワゴン 価格(税抜)サイズ(mm)梱包才数梱包重量
NDW-19L 30,000円 W500×D315×H1901.7才3.6kg 仕様/本体:スチ-ル 粉体塗装 (ホワイト) キャスタ-:ストッパ-付2個、ストッパ-無2個 入数:1 ●棚板有効内寸:W468×D296 ●棚板は、斜め又は水平に取付可能です。 ●棚の入れ替えは工具無しで 簡単に行えます。
フロアケース



取り出し易いよう、 各棚板に指穴がついています。
フロアケース 価格(税抜)サイズ(mm)梱包才数梱包重量
KAW-12 22,000円 W275×D350×H9000.9才9kg
KAW-13 28,000円 W480×D350×H9001.7才14kg
仕様/本体:パ-ティクルボ-ド プリント化粧板貼り 入数:1 ●棚板有効内寸:233×330 (A4サイズ対応)・ ●棚板有効内寸:439×330 (A3サイズ対応) ●可動スライド板9枚付 ●ネ-ムプレ-ト付 ●30mmピッチ で棚位置を変更できます。
ファイルスタンド

ファイルスタンド 価格(税抜)サイズ(mm)梱包才数梱包重量
KBS-50 32,000円 W500×D240×H5500.3才5kg
KBS-70 35,000円 W700×D240×H5500.4才6kg
KBS-80 36,000円 W800×D240×H5500.4才6.5kg
仕様/本体:スチ-ル 粉体塗装 (ホワイトグレ-) 棚板:スチ-ル 粉体塗装 入数:1 ●(トレ-内寸・上: W480×D210×H222/下:W480×D210×H310)・●(トレ-内寸・上:W680×D210×H222/下:W680× D210×H310)・●(トレ-内寸・上:W780×D210×H222/下:W780×D210×H310)

アンダーデスクワゴン 価格(税抜)サイズ(mm)梱包才数梱包重量
NDW-45BT 43,000円 W465×D260×H6001.1才8.3kg
仕様/本体:スチ-ル 粉体塗装 (ホワイト) サポ-ト・フック:スチ-ル フレ-ム:スチ-ル (〼19mm) サポ- トレ-ル:アルミ 入数:1 ●棚板・底板有効寸法:W402×D259 ●スライド棚有効内寸:W140×D220 ●下段はファイルをしっかり押さえる事ができるサポ-ト1個付 ●カバン等を掛けれるフック1個付 ●ゴミ箱やカ バン等を置く事ができるスライドタイプのトレ-付 (片側のみ) ●キャスタ-:ストッパ-付2個、ストッパ-無2個

YA4PT-118N

YA4PT-209N
フロアケース 価格(税抜)サイズ(mm)梱包才数梱包重量
YA4PT-109N 67,000円 W303×D401×H8804.5才17kg
YA4PT-118N 77,900円 W303×D401×H8804.5才18kg
YA4PT-209N 113,000円 W590×D401×H8808.7才26kg
YA4PT-218N 139,000円 W590×D401×H8808.7才 ▲ 30kg
仕様/本体:スチ-ル 粉体塗装 (ホワイト) 引出:ポリスチレン樹脂 入数:1 ●引出内寸:W254×D335×
H80・●引出内寸:W256×D337×H36
フリーボックス


幼保レンタル・リース

フリーボックス 価格(税抜)サイズ(mm)梱包才数梱包重量
FB-3 52,000円 W300×D515×H8805.9才13kg 仕様/本体:スチ-ル 扉:ABS樹脂 入数:1 ●連結穴加工 (ビス/キャップ付) ●名札差し ●鍵付(各段2個付) ●1扉あたりの有効内寸:234×479×248mm
使用例
NDW-19L
NDW-45BT
KAW-12
KAW-13
KBS-70
FB-3(WH) FB-3(BL) FB-3(PK)
147 SOCIA
Partition

QSB
Reception

Exterior
吸音効果のあるパネルで簡易に個人ブースが作れます。

QSB説明(レイアウト寸法図)
■残響室法吸音率試験
人の声に多く含まれる周波数帯域(500~1000Hz)の吸音率 が0.5~0.75と高水準で、高い吸音性能を有しています。
※�測定結果はパネル単体での物性評価です。 ※�実際の吸音効果をお約束するものではありません。
試験年月日:2022年8月24日
QSB説明(レイアウト寸法図)
■吸音材適用効果検証試験
スピーカー音響出力を人の聴覚が最も敏感な周波数帯 (1000Hz)で吸音材無しと吸音材有り(QSB)で試験を 実施した結果、5dB 音漏れが軽減された。
特定周波数帯における音圧レベルのコンター図




1000 1000 425 970 1000 1000 970 600 710 575 吸音集中ブース (レイアウト寸法図) 2023.4.18 作成 1000 1425 1000 1000 970 計測 800Hz帯 1600Hz帯 吸音材無し (QSB) 吸音材有り
吸音集中ブース
1/3オクターブバンド中心周波数[Hz] 125250500100020004000 残響室法吸音率 1.1 1.0 0.9 0.8 0.7 0.6 0.5 0.4 0.3 0.2 0.1 0.0
騒音レベル 小 大
QSB-1810T(GN)セット例
QSB-1510(BL)セット例
QSB-1810T(GN-GN)
QSB-1810T(BL-GR)
QSB-1810T(GN-GR) ASO-OC1(GR)
148
G-TN18
テーブル
レセプション
Table
ロビー
エクステリア
Lobby
アクセサリー
Accessories
レンタル・リース
Woodworking Welfare Kindergarten
気になる周りの視線や話し声を抑えることで集中できるブースを
■単色カラーサンプル
チェアデスク・収納パーティションテーブルレセプションロビーエクステリアアクセサリー木工

BL:ブルー BJ:ベージュ

GN:グリーン


GR:グレー

単色カラー H1800扉付タイプ


■ツートンカラーサンプル


GR:グレー GR:グレー GR:グレー BJ:ベージュ BL:ブルー GN:グリーン




ツートンカラー H1800扉付タイプ

吸音集中ブース (扉付) 価格(税抜) サイズ(mm) 梱包才数梱包重量
QSB-1810T 376,000円 W1044×D1447×H1800 ▲ 12.7才 54kg
仕様/本体:表面布張り (ポリエステル100%) 吸音不織布 枠:塩ビ成型品 入数:1(5個口)
単色カラー H1500タイプ(コ型) ツートンカラー H1500タイプ(コ型)

一人用デスク・テーブル

カラーサンプルは、 P.049をご参照ください。
ワークデスク 価格(税抜) サイズ(mm) 梱包才数梱包重量
ASO-WD6050B 72,000円 W600×D500×H720 5.2才 16.1kg
仕様/天板:抗ウイルスメラミン化粧板 (t22mm) 抗ウイルスABSエッジ (SGRは通常ABS) 天板裏:抗ウイルスバッカ- 本体:抗ウイルスメラミ ン化粧板 脚:スチ-ル 粉体塗装 (ブラック) 入数:1(2個口)


吸音集中ブース 価格(税抜) サイズ(mm) 梱包才数梱包重量
QSB-1510 269,000円 W1044×D1022×H1500 ▲ 9.1才 39kg
仕様/本体:表面布張り (ポリエステル100%) 吸音不織布 枠:塩ビ成型品 入数:1(4個口)

カラーサンプルは、 P.049をご参照ください。
ワークテーブル 価格(税抜) サイズ(mm) 梱包才数梱包重量 ASO-WT6045B 60,000円 W600×D450×H720 2.2才 15.7kg 仕様/天板:抗ウイルスメラミン化粧板 (t22mm) 抗ウイルスABSエッジ (SGRは通常ABS) 天板裏:抗ウイルスバッカ- 脚:スチ-ル 粉体塗装 (ブラック) 入数:1(2個口)
幼保レンタル・リース

カラーサンプルは、 P.219をご参照ください。
抗ウイルスフォール ディングテーブル 価格(税抜) サイズ(mm) 梱包才数梱包重量
AHM-6545VH 66,500円 W650×D450×H720 1.7才 12kg 仕様/天板:抗ウイルスメラミン化粧板 (t21mm) 抗ウイルスABSエッジ 天板裏:抗ウイルスバッカ- 脚:スチ-ル 粉体塗装 (ホワイト) キャス タ-:PU (φ50mm) 入数:1 ●脚間内寸:W427×D440 ●棚付 ●天板跳ね上げ機能付 ●平行スタッキング可能 ●キャスタ-:昇降機 能付アジャスタ- (ストッパ-付2個、ストッパ-無2個) ●両側フック付
ASO-WD6050B(MAK)
ASO-WT6045B(SGR)
AHM-6545VH(BR)
外 内
QSB-1510(BL-BL)
ASO-OC1(GR)
QSB-1810T(BJ-GR)
QSB-1510(BJ-GR)
QSB-1810T(BL)
QSB-1510(BL)
QSB-1810T(BJ)
QSB-1510(GN)
149 SOCIA
MPBシリーズ


パネルの工具レス連結 上部用と下部用の連結樹脂 セットで簡単に連結できます。








※脚部組み付け時の高さは、アジャスター仕様が+41mm、キャスター仕様が+86mmになります。
45° 支柱 支柱 連結樹脂(上部用) キャップ 支柱 45° 連結樹脂(下部用) キャップ 支柱 連結樹脂(上部用) キャップ 支柱 45° 支柱 支柱 連結樹脂(上部用) キャップ 支柱
ポリカーボネイト ナチュラル ベージュ ブルー グレー グリーン オレンジ ■布カラーサンプル
ライトグリーン ■強化紙カラーサンプル
FDC-2412B(NA)
MPB-F
MPB-1809FAR
CK02(OR)
MPB-1809A(NA)
ASO-BLS(IV) ASO-OT1260(MAK)
LKC-580(IV)
MPB-F
150
MPB-1806F

H1800mm
チェアデスク・収納パーティションテーブルレセプションロビーエクステリアアクセサリー木工


H1500mm

パネルA (全面布) 価格(税抜)サイズ(mm)梱包才数梱包重量
MPB-1812A 77,000円 W1200×H1765 ▲ 3.6才 11kg
MPB-1809A 68,000円 W900×H1765 ▲ 2.9才 9kg
MPB-1806A 55,000円 W600×H17651.8才
仕様/パネル:フラッシュ合板 表面布張り(ナチュラルは強化紙) パネル枠:塩ビ成型品 パネル厚:30mm 入数:1 ※ピン・マグネット使用できません。
H1200mm





パネルA (全面布) 価格(税抜)サイズ(mm)梱包才数梱包重量
MPB-1512A 69,000円 W1200×H1465 ▲ 3.0才9kg
MPB-1509A 63,000円 W900×H14652.3才8kg
MPB-1508A 61,000円 W800×H14652.0才7kg
MPB-1507A 60,000円 W700×H14651.8才6kg
MPB-1506A 53,000円 W600×H14651.5才6kg

パネルA (全面布) 価格(税抜)サイズ(mm)梱包才数梱包重量
アクリルパネルH1800・H1500mm


パネルU (上部透明) 価格(税抜)サイズ(mm)梱包才数梱包重量
MPB-1809UAR 112,000円 W900×H1765 ▲ 2.7才10kg
MPB-1509UAR 100,000円 W900×H14652.3才8kg
仕様/パネル:フラッシュ合板 表面布張り(ナチュラルは強化紙) パネル枠:塩ビ成型品
パネル透明部:アクリル (t1.8mm) パネル厚:30mm 入数:1 ※ピン・マグネット使用できません。 ※上部透明部分の大きさはパネルサイズによって異なります。
MPB-1207A 54,000円 W700×H11651.4才 5kg
MPB-1206A 43,000円 W600×H11651.2才 5kg
仕様/パネル:フラッシュ合板 表面布張り(ナチュラルは強化紙) パネル枠:塩ビ成型品 パネル厚:30mm 入数:1 ※ピン・マグネット使用できません。
ポリカーボネイト



パネルF (全面透明) 価格(税抜)サイズ(mm)梱包才数梱包重量
MPB-1809FAR 89,000円 W900×H1765 ▲ 2.7才11kg
MPB-1509FAR 86,000円 W900×H14652.3才10kg
仕様/パネル枠:塩ビ成型品 パネル透明部:アクリル (t1.8 mm) パネル厚:30mm 入数:1
仕様/パネル:フラッシュ合板 表面布張り(ナチュラルは強化紙) パネル枠:塩ビ成型品 パネル厚:30mm 入数:1 ※ピン・マグネット使用できません。 パネルU
MPB-1509U 97,000円 W900×H14652.3才 7kg
MPB-1212U 90,000円 W1200×H11652.4才 8kg
MPB-1209U 78,000円 W900×H11651.8才 5kg



幼保レンタル・リース
パネルF (全面半透明) 価格(税抜)サイズ(mm)梱包才数梱包重量
MPB-1812F 129,000円 W1200×H1765 ▲ 3.6才11kg
MPB-1809F 107,000円 W900×H1765 ▲ 2.7才 7kg
MPB-1512F 114,000円 W1200×H1465 ▲ 3.0才 8kg
MPB-1509F 96,000円 W900×H14652.3才 6kg
MPB-1212F 100,000円 W1200×H11652.4才 7kg
MPB-1209F 87,000円 W900×H11651.8才 5kg
仕様/パネル:フラッシュ合板 表面布張り(ナチュラルは強化紙) パネル枠:塩ビ成型品 パネル透明部:ポリカ-ボネイト (t6mm) パネル厚:30mm 入数:1 ※ピン・マグネット使用できません。 ※上部透明部分の大きさはパネルサイズによってそれぞれ異なります。
仕様/パネル枠:塩ビ成型品 パネル透明部:ポリカ-ボネイト (t6 mm) パネル厚:30mm 入数:1
価格(税抜)サイズ(mm)梱包才数梱包重量 MPB-1812U 129,000円 W1200×H1765 ▲ 3.6才 11kg MPB-1809U 100,000円 W900×H1765 ▲ 2.7才 8kg MPB-1512U 102,000円 W1200×H1465 ▲ 3.0才 10kg
(上部半透明)
MPB-1812A(ナチュラル) MPB-1809A(ブルー)
MPB-1806A(グリーン)
MPB-1512A(ベージュ) MPB-1509A(グレー) MPB-1506A(オレンジ)
MPB-1212A(ブルー) MPB-1209A(グリーン)MPB-1207A(ベージュ)
MPB-1509UAR(オレンジ)+MPB-F×2
MPB-1809FAR+MPB-FK×2
MPB-1812U(ライトグリーン)MPB-1509U(ベージュ)
940mm 全サイズ 共通
パネル部(半透明)
MPB-1209U(グレー)
パネル部(半透明)
MPB-1812F
8kg
MPB-1212A 67,000円 W1200×H11652.4才 8kg MPB-1209A 56,000円 W900×H11651.8才 6kg MPB-1208A 55,000円 W800×H11651.6才 6kg
151 SOCIA
防炎タイプ MPBシリーズ
H1800

防炎製品 ではありま せん。

■カラーサンプル(防炎加工布)



中身・構造体は防炎素材ではありません。

グレー ベージュ オレンジ グリーン ブルー

パネルA (全面布) 価格(税抜)サイズ(mm)梱包才数梱包重量
MPB-1812AB 84,000円 W1200×H1765 ▲ 3.6才 11kg
MPB-1809AB 75,000円 W900×H1765 ▲ 2.7才 9kg
MPB-1806AB 59,000円 W600×H17651.8才 8kg 仕様/パネル:フラッシュ合板 表面布張り パネル枠:塩ビ成型品 パネル厚:30mm 入数:1 ※ピン・マグネット使用できません。


H1200 H1500 アクリル H1800・H1500



パネルA (全面布) 価格(税抜)サイズ(mm)梱包才数梱包重量
MPB-1212AB 72,000円 W1200×H11652.4才 8kg
MPB-1209AB 60,000円 W900×H11651.8才 6kg
MPB-1208AB 58,000円 W800×H11651.6才 6kg
MPB-1207AB 58,000円 W700×H11651.4才 5kg
MPB-1206AB 46,000円 W600×H11651.2才 5kg
仕様/パネル:フラッシュ合板 表面布張り パネル枠:塩ビ成型品 パネル厚:30mm 入数:1 ※ピン・マグネット使用できません。
ポリカーボネイト H1800H1500H1200


パネルA (全面布) 価格(税抜)サイズ(mm)梱包才数梱包重量
MPB-1512AB 74,000円 W1200×H1465 ▲ 3.0才 9kg
MPB-1509AB 69,000円 W900×H14652.3才 8kg
MPB-1508AB 67,000円 W800×H14652.0才 7kg
MPB-1507AB 66,000円 W700×H14651.8才 6kg
MPB-1506AB 57,000円 W600×H14651.5才 6kg
仕様/パネル:フラッシュ合板 表面布張り パネル枠:塩ビ成型品 パネル厚:30mm 入数:1 ※ピン・マグネット使用できません。


パネルU (上部透明) 価格(税抜)サイズ(mm)梱包才数梱包重量
MPB-1809UARB 115,000円 W900×H1765 ▲ 2.7才10kg
MPB-1509UARB 103,000円 W900×H14652.3才8kg
仕様/パネル:フラッシュ合板 表面布張り パネル枠:塩ビ成型品 パネル透明部:アクリル (t1.8mm) パネル厚: 30mm 入数:1 ※ピン・マグネット使用できません。 ※上部透明部分の大きさはパネルサイズによって異なります。

1800mm




パネルF (全面半透明) 価格(税抜)サイズ(mm)梱包才数梱包重量
MPB-1812F 129,000円 W1200×H1765 ▲ 3.6才11kg
MPB-1809F 107,000円 W900×H1765 ▲ 2.7才7kg
MPB-1512F 114,000円 W1200×H1465 ▲ 3.0才8kg
MPB-1509F 96,000円 W900×H14652.3才6kg
MPB-1212F 100,000円 W1200×H11652.4才7kg
MPB-1209F 87,000円 W900×H11651.8才5kg
仕様/パネル枠:塩ビ成型品 パネル透明部:ポリカ-ボネイト (t6 mm) パネル厚:30mm 入数:1
パネルU (上部半透明) 価格(税抜)サイズ(mm)梱包才数梱包重量 MPB-1812UB 129,000円 W1200×H1765 ▲ 3.6才11kg MPB-1809UB 103,000円 W900×H1765 ▲ 2.7才8kg MPB-1512UB 105,000円 W1200×H1465 ▲ 3.0才10kg MPB-1509UB 100,000円 W900×H14652.3才7kg MPB-1212UB 92,000円 W1200×H11652.4才8kg MPB-1209UB 81,000円 W900×H11651.8才5kg 仕様/パネル:フラッシュ合板 表面布張り パネル枠:塩ビ成型品 パネル透明部:ポリカ-ボネイト (t6mm) パネル 厚:30mm 入数:1 ※ピン・マグネット使用できません。 ※上部透明部分の大きさはパネルサイズによって異なります。
MPB-1812UB(グリーン)
MPB-1509UB(ベージュ)MPB-1209UB(グレー)
MPB-1212F
パネル部(半透明)
MPB-1212AB(ブルー) MPB-1212AB(グリーン)
MPB-1212AB(ベージュ)
MPB-1509UARB(グリーン)+MPB-F×2
MPB-1509UARB(グレー)+MPB-F×2
MPB-1812AB(オレンジ)
MPB-1812AB(ブルー) MPB-1812AB(グリーン)
MPB-1512AB(ベージュ) MPB-1512AB(グレー)
MPB-1512AB(オレンジ)
152
可動連結セット例
■セット例①
MPB-1812A 77,000円×1
MPB-1809A 68,000円×2
チェアデスク・収納パーティションテーブルレセプションロビーエクステリアアクセサリー木工
MPB-JK18 13,500円×2
MPB-FK 6,500円×2
MP-K 2,500円×2
合計258,000円(税別)
2方向連結


※パネル3枚までの連結は、完組品出荷が可能です。 4連以上の連結はお問い合わせください。

■セット例②
MPB-1812A 77,000円×1
MPB-1809F 107,000円×1
MPB-JK18 13,500円×1


安定脚

3方向連結

MPB-FK 6,500円×2

MP-K 2,500円×1
合計213,000円(税別)



安定脚 価格(税抜)サイズ(mm)
MPB-FK 6,500円 W420×H83
MPB-F 5,500円 W420×H37 仕様/本体:アルミダイカスト 入数:1 ●ストッパ-付1個、ストッパ-無1個
可動連結

MPB-JK18
可動連結セット (2方向) 価格(税抜) サイズ(mm) 梱包重量
MPB-JK18 13,500円 W12×H1761 3kg
MPB-JK15 13,000円 W12×H1461 2kg
MPB-JK12 10,000円 W12×H1161 1.5kg
仕様/本体:スチ-ル 粉体塗装 入数:1

4方向連結


簡易固定連結樹脂 セット 価格(税抜) サイズ(mm)

MPB-2J 3,000円 上部用:W61×D30×H46.2/下部用:W61×D30×H87.2
MPB-3J 4,000円 上部用:W61×D61×H46.2/下部用:W61×D61×H87.2

MPB-4J 5,000円 上部用:W83.7×D61×H46.2/下部用:W83.7×D61×H87.2 仕様/本体:樹脂成型品 入数:1 ●角度45°ピッチで設定可能
キャスター脚/アジャスター脚


キャスター脚/アジャスター脚 価格(税抜) サイズ(mm)
MP-K 2,500円 H86
MP-AJ 800円 H35
仕様/本体:樹脂成型品 入数:1 ※パネル1枚のみでのご使用はできません。 ●ストッパ-付
フック/ハンガー



幼保レンタル・リース
MPシリーズオプション 価格(税抜) サイズ(mm) 梱包重量
MP-J 4,100円 W50×D36×H85 0.1kg
MP-H 5,000円 W70×D83.5×H1220.2kg
仕様/ 入数:1
パンフレット ケース 価格(税抜)サイズ(mm)梱包才数梱包重量
PCP-102 16,000円 W235×D120×H7700.4才 2kg
仕様/本体:スチ-ル 粉体塗装 (シルバ-) ケ-ス:樹脂成型品 入数:1 ●付属のサイズチェンジパ-ツ を使えば、A4以下 (DM・A5・A6・B5・B6・ハガキ) が収納可能です。 ●パ-ティションフック可動域:25~ 55mmまで調整可能です。
MP-J(フック) MP-H(ハンガー) PCP-102(WH)(パンフレットケース)
キャスター脚
アジャスター脚
安定脚(キャスター付) MPB-FK 安定脚(アジャスター付) MPB-F
MP-K
MP-AJ
MPB-3J(上部)
MPB-2J(上部)
MPB-4J(下部)
MPB-3J(下部)
MPB-2J(下部)
153 SOCIA
MPB-4J(上部)
防炎タイプ

ポリカーボネイト
W3000×H1800

セット内訳 数景 価格
MPB-1812AB(ブルー) 1 84,000円
MPB-1809AB(ブルー) 2 75,000円
MPB-JK18
MPB-FK
2 13,500円
2 6,500円
MP-K 2 2,500円 合計価格(税抜き) 279,000円
W2100×H1500

セット内訳 数景 価格 MPB-1509AB(グリーン) 1 69,000円
MPB-1506AB(グリーン) 2 57,000円 MPB-JK15 2 13,000円
MPB-FK 2 6,500円
MP-K 2 2,500円 合計価格(税抜き) 227,000円
W2400×H1500
セット内訳 数景 価格 MPB-1812AB(オレンジ) 1 84,000円
MPB-1809AB(オレンジ) 1 75,000円
MPB-1809F1 107,000円
MPB-JK18 2 13,500円
MPB-FK 2 6,500円
MP-K 2 2,500円 合計価格(税抜き) 227,000円

セット内訳 数景 価格 MPB-1509AB(ベージュ) 1 69,000円 MPB-1506AB(ベージュ) 1 57,000円
MPB-1509F1 96,000円
MPB-JK15 2 13,000円
MPB-FK 2 6,500円
MP-K 2 2,500円 合計価格(税抜き) 288,000円
通常タイプ
W3000×H1800

W2100×H1800
セット内訳 数景 価格
MPB-1812A(ブルー)1 77,000円
MPB-1809A(ブルー)2 68,000円
MPB-JK18 2 13,500円
MPB-FK 2 6,500円
MP-K
2 2,500円 合計価格(税抜き) 258,000円

W3000×H1500

セット内訳 数景 価格
MPB-1512A(ベージュ) 1 69,000円
MPB-1509A(ベージュ) 2 63,000円
MPB-JK15 2 13,000円
MPB-FK 2 6,500円
MP-K 2 2,500円 合計価格(税抜き) 239,000円
W2100×H1500

セット内訳 数景 価格
MPB-1509A(グレー)1 63,000円 MPB-1506A(グレー)2 53,000円 MPB-JK15 2 13,000円
MPB-FK 2 6,500円
MP-K 2 2,500円 合計価格(税抜き) 213,000円

セット内訳 数景 価格 MPB-1809A(グリーン) 1 68,000円 MPB-1806A(グリーン) 2 55,000円 MPB-JK18 2 13,500円 MPB-FK 2 6,500円 MP-K 2 2,500円 合計価格(税抜き) 223,000円
W3000×H1800
三連パネル
154
MPシリーズ
45°ピッチで連結角度の設定が可能!
チェアデスク・収納パーティションテーブルレセプションロビーエクステリアアクセサリー木工


パネルの工具レス連結 上部用と下部用の連結樹脂 セットで簡単に連結できます。







幼保レンタル・リース
※脚部組み付け時の高さは、アジャスター仕様が+41mm、キャスター仕様が+86mmになります。
45° 支柱 支柱 連結樹脂(上部用) キャップ 支柱 45° 支柱 連結樹脂(下部用) キャップ 支柱 連結樹脂(上部用)
支柱 45° 支柱 支柱 連結樹脂(上部用) キャップ 支柱
キャップ
MP-1809FAR+MP-F
ASO-S9045B(NA)
YSC01(GN)
MP-1809A(ライトグリーン)
ALES-CTB(BR)
デスク FDC-2412W(NA) P.204
チェア CK02(OR) P.080
ベージュ ライトグリーン ブルー グレー グリーン オレンジ ■カラーサンプル
SOCIA G-MS18 P.070
ポリカーボネイト
155 SOCIA
H1800mm



パネルA (全面布) 価格(税抜)サイズ(mm)梱包才数梱包重量
MP-1812A 77,000円 W1200×H1765
MP-1809A 68,000円 W900×H1765
▲ 3.6才 11kg
▲ 2.9才 9kg
MP-1806A 55,000円 W600×H17651.8才 8kg
仕様/パネル:フラッシュ合板 表面布張り パネル枠:塩ビ成型品 パネル厚:30mm 入数:1 ※ピン・マグネット使用できません。
H1200mm



パネルA (全面布) 価格(税抜)サイズ(mm)梱包才数梱包重量
MP-1212A
MP-1208A
MP-1207A
円
5kg
MP-1206A 43,000円 W600×H11651.2才 5kg 仕様/パネル:フラッシュ合板 表面布張り パネル枠:塩ビ成型品 パネル厚:30mm 入数:1 ※ピン・マグネット使用できません。
ポリカーボネイト


940mm 全サイズ

H1500mm



パネルA (全面布) 価格(税抜)サイズ(mm)梱包才数梱包重量
MP-1512A 69,000円 W1200×H1465 ▲ 3.0才9kg
MP-1509A 63,000円 W900×H14652.3才8kg
MP-1508A 61,000円 W800×H14652.0才7kg
MP-1507A 60,000円 W700×H14651.8才6kg
MP-1506A 53,000円 W600×H14651.5才6kg
仕様/パネル:フラッシュ合板 表面布張り パネル枠:塩ビ成型品 パネル厚:30mm 入数:1 ※ピン・マグネット使用できません。
アクリルパネルH1800・H1500mm


パネルU (上部透明) 価格(税抜)サイズ(mm)梱包才数梱包重量
MP-1809UAR 112,000円 W900×H1765 ▲ 2.7才10kg
MP-1509UAR 100,000円 W900×H14652.3才8kg
仕様/パネル:フラッシュ合板 表面布張り パネル枠:塩ビ成型品 パネル透明部:アクリル (t1.8mm) パネル厚:30mm 入数:1 ※ピン・マグネット使用できません。 ※上部透明部分の大きさはパネルサイズ によって異なります。
パネルF (全面透明) 価格(税抜)サイズ(mm)梱包才数梱包重量
MP-1809FAR 89,000円 W900×H1765 ▲ 2.7才11kg
MP-1509FAR 86,000円 W900×H14652.3才10kg
仕様/パネル枠:塩ビ成型品 パネル透明部:アクリル (t1.8mm) パネル厚:30mm 入数:1

パネルU (上部半透明)
MP-1812U
MP-1212U
8kg
MP-1209U 78,000円 W900×H11651.8才 5kg
仕様/パネル:フラッシュ合板 表面布張り パネル枠:塩ビ成型品 パネル透明部:ポリカ-ボネイト (t6mm) パネル厚:30mm 入数:1 ※ピン・マグネット使用できません。 ※上部透明部分の大きさはパネルサイズによって それぞれ異なります。


パネルF (全面半透明) 価格(税抜)サイズ(mm)梱包才数梱包重量
MP-1812F 129,000円 W1200×H1765 ▲ 3.6才11kg
MP-1809F 107,000円 W900×H1765 ▲ 2.7才7kg
MP-1512F 114,000円 W1200×H1465 ▲ 3.0才8kg
MP-1509F 96,000円 W900×H14652.3才6kg
MP-1212F 100,000円 W1200×H11652.4才7kg
MP-1209F 87,000円 W900×H11651.8才5kg
仕様/パネル枠:塩ビ成型品 パネル透明部:ポリカ-ボネイト (t6mm) パネル厚:30mm 入数:1
価格(税抜)サイズ(mm)梱包才数梱包重量
125,000円 W1200×H1765 ▲ 3.6才11kg
100,000円 W900×H1765 ▲ 2.7才 8kg MP-1512U 102,000円 W1200×H1465 ▲ 3.0才10kg
97,000円 W900×H14652.3才 7kg
MP-1809U
MP-1509U
90,000円 W1200×H11652.4才
67,000円 W1200×H11652.4才 8kg
56,000
W900×H11651.8才 6kg
MP-1209A
円
55,000
W800×H11651.6才
円
6kg
54,000
W700×H11651.4才
MP-1812A(オレンジ) MP-1809A(ブルー)
MP-1806A(グリーン)
MP-1512A(ベージュ) MP-1509A(グレー) MP-1506A(ライトグリーン)
MP-1212A(ブルー) MP-1209A(グリーン)MP-1207A(ベージュ) MP-1509UAR(オレンジ)+MP-F×2
MP-1809FAR+MP-FK×2
MP-1812U(ライトグリーン)MP-1509U(ベージュ)
MP-1209U(グレー)
共通
パネル部(半透明) パネル部(半透明)
156
MP-1812F
防炎製品 ではありま せん。
チェアデスク・収納パーティションテーブルレセプションロビーエクステリアアクセサリー木工




パネルA (全面布) 価格(税抜)サイズ(mm)梱包才数梱包重量
MP-1812AB 84,000円 W1200×H1765
MP-1806AB 59,000円 W600×H17651.8才 8kg 仕様/パネル:フラッシュ合板 表面布張り パネル枠:塩ビ成型品 パネル厚:30mm 入数:1 ※ピン・マグネット使用できません。
防炎タイプ MPシリーズ H1800 H1200 H1500



パネルA (全面布) 価格(税抜)サイズ(mm)梱包才数梱包重量
MP-1212AB 72,000円 W1200×H11652.4才 8kg
MP-1209AB 60,000円 W900×H11651.8才 6kg
MP-1208AB 58,000円 W800×H11651.6才 6kg
MP-1207AB 58,000円 W700×H11651.4才 5kg
MP-1206AB 46,000円 W600×H11651.2才 5kg
仕様/パネル:フラッシュ合板 表面布張り パネル枠:塩ビ成型品 パネル厚:30mm 入数:1 ※ピン・マグネット使用できません。
ポリカーボネイト H1800H1500H1200









パネルA (全面布) 価格(税抜)サイズ(mm)梱包才数梱包重量
MP-1512AB 74,000円 W1200×H1465 ▲ 3.0才 9kg
MP-1509AB 69,000円 W900×H14652.3才 8kg
MP-1508AB 67,000円 W800×H14652.0才 7kg
MP-1507AB 66,000円 W700×H14651.8才 6kg
MP-1506AB 57,000円 W600×H14651.5才 6kg
仕様/パネル:フラッシュ合板 表面布張り パネル枠:塩ビ成型品 パネル厚:30mm 入数:1 ※ピン・マグネット使用できません。
アクリル H1800・H1500


パネルU (上部透明) 価格(税抜)サイズ(mm)梱包才数梱包重量
MP-1809UARB 115,000円 W900×H1765 ▲ 2.7才 10kg
MP-1509UARB 103,000円 W900×H14652.3才 8kg
仕様/パネル:フラッシュ合板 表面布張り パネル枠:塩ビ成型品 パネル透明部:アクリル (t1.8mm) パネル厚:30mm 入数:1 ※ピン・マグネット使用できません。 ※上部透明部分の大きさはパネルサイズに よって異なります。

W1200×H1465 ▲ 3.0才10kg
MP-1509UB 100,000円 W900×H14652.3才 7kg
MP-1212UB 92,000円 W1200×H11652.4才 8kg
MP-1209UB 81,000円 W900×H11651.8才 5kg
仕様/パネル:フラッシュ合板 表面布張り パネル枠:塩ビ成型品 パネル透明部:ポリカ-ボネイト (t6mm) パネル厚:30mm 入数:1 ※ピン・マグネット使用できません。 ※上部透明部分の大きさはパネルサイズによっ て異なります。

幼保レンタル・リース

パネルF (全面半透明) 価格(税抜)サイズ(mm)梱包才数梱包重量
MP-1812F 129,000円 W1200×H1765 ▲ 3.6才11kg
MP-1809F 107,000円 W900×H1765 ▲ 2.7才 7kg
MP-1512F
(t6mm) パネル厚:30mm 入数:1
1500mm 1800mm 1200mm
▲
3.6才 11kg
MP-1809AB 75,000円 W900×H1765 ▲ 2.7才 9kg
(上部半透明) 価格(税抜)サイズ(mm)梱包才数梱包重量 MP-1812UB 129,000円 W1200×H1765 ▲ 3.6才11kg MP-1809UB 103,000円 W900×H1765 ▲ 2.7才 8kg
105,000円
パネルU
MP-1512UB
114,000円 W1200×H1465 ▲ 3.0才 8kg MP-1509F 96,000円 W900×H14652.3才 6kg MP-1212F 100,000円 W1200×H11652.4才 7kg MP-1209F 87,000円 W900×H11651.8才 5kg 仕様/パネル枠:塩ビ成型品 パネル透明部:ポリカ-ボネイト
MP-1812UB(グリーン)
MP-1509UB(ベージュ)
MP-1209UB(グレー)
MP-1212F
パネル部(半透明)
MP-1212AB(ブルー)
MP-1212AB(グリーン)
MP-1212AB(ベージュ)
1509UARB(グリーン)+MP-F×2
MP-1509UARB(グレー)+MP-F×2
MP-1812AB(オレンジ)
MP-1812AB(ブルー)
MP-1812AB(グリーン)
MP-1512AB(ベージュ)
MP-1512AB(グレー)
MP-1512AB(オレンジ)
中身・構造体は防炎素材ではありません。 グレー ベージュ オレンジ グリーン ブルー
157 SOCIA
■カラーサンプル(防炎加工布)
可動連結セット例
■セット例①
MP-1812A 77,000円×1
MP-1809A 68,000円×2
MP-JK18 13,500円×2
MP-FK 6,500円×2
MP-K 2,500円×2
合計258,000円(税別)
2方向連結

MP-2J(上部)

MP-2J(下部)
※パネル3枚までの連結は、完組品出荷が可能です。 4連以上の連結はお問い合わせください。



3方向連結

MP-3J(上部)

MP-3J(下部)
■セット例②
MP-1812A 77,000円×1
MP-1809F 107,000円×1
MP-JK18 13,500円×1
MP-FK 6,500円×2
MP-K 2,500円×1
合計213,000円(税別)



4方向連結

MP-4J(上部)

MP-4J(下部)
簡易固定連結樹脂セット 価格(税抜) サイズ(mm)


MP-2J 3,000円 上部用:W61×D30×H46.2/下部用:W61×D30×H87.2
MP-3J 4,000円 上部用:W61×D61×H46.2/下部用:W61×D61×H87.2
MP-4J 5,000円 上部用:W83.7×D61×H46.2/下部用:W83.7×D61×H87.2 仕様/本体:樹脂成型品 入数:1 ●角度45°ピッチで設定可能
安定脚


価格(税抜)
サイズ(mm)
MP-FK 6,500円 W420×H83
MP-F 5,500円 W420×H37 仕様/本体:アルミダイカスト 入数:1 ●ストッパ-付1個、ストッパ-無1個
可動連結

可動連結セット (2方向) 価格(税抜)サイズ(mm)梱包重量
MP-JK18 13,500円 W12×H17613kg
MP-JK15 13,000円 W12×H14612kg
MP-JK12 10,000円 W12×H11611.5kg
仕様/本体:スチ-ル 粉体塗装 入数:1
キャスター脚/アジャスター脚


キャスター脚/アジャスター脚 価格(税抜) サイズ(mm)
MP-K 2,500円 H86
MP-AJ 800円 H35
仕様/本体:樹脂成型品 入数:1 ※パネル1枚のみでのご使用はできません。 ●ストッパ-付
フック/ハンガー



MPシリーズオプション 価格(税抜) サイズ(mm)梱包重量
MP-J 4,100円 W50×D36×H850.1kg
MP-H 5,000円 W70×D83.5×H1220.2kg
仕様/ 入数:1
パンフレット
ケース 価格(税抜)サイズ(mm)梱包才数梱包重量 PCP-102 16,000円 W235×D120×H7700.4才 2kg 仕様/本体:スチ-ル 粉体塗装 (シルバ-) ケ-ス:樹脂成型品 入数:1 ●付属のサイズチェンジパ-ツ を使えば、A4以下 (DM・A5・A6・B5・B6・ハガキ) が収納可能です。 ●パ-ティションフック可動域:25~ 55mmまで調整可能です。
安定脚
MP-JK18
安定脚(キャスター付) MP-FK 安定脚(アジャスター付) MP-F キャスター脚 MP-K アジャスター脚 MP-AJ
MP-J(フック) MP-H(ハンガー) PCP-102(WH)(パンフレットケース)
158
防炎タイプ

ポリカーボネイト
W3000×H1800

通常タイプ
W3000×H1800


セット内訳 数景 価格
MP-1812A(Bブルー)1 84,000円
MP-1809A(Bブルー)2 75,000円
MP-JK18 2 13,500円
MP-FK 2 6,500円
MP-K 2 2,500円 合計価格(税抜き) 279,000円

セット内訳 数景 価格
MP-1812A(Bオレンジ) 1 84,000円
MP-1809A(Bレンジ)1 75,000円
MP-1809F 1 107,000円
MP-JK18 2 13,500円
MP-FK 2 6,500円
MP-K 2 2,500円 合計価格(税抜き) 227,000円

セット内訳 数景 価格
MP-1509A(Bグリーン) 1 69,000円
MP-1506A(Bグリーン) 2 57,000円
MP-JK15 2 13,000円
MP-FK 2 6,500円
MP-K 2 2,500円 合計価格(税抜き) 227,000円
セット内訳 数景 価格
MP-1812A(ブルー)1 77,000円
MP-1809A(ブルー)2 68,000円
MP-JK18 2 13,500円
MP-FK 2 6,500円
MP-K 2 2,500円 合計価格(税抜き) 258,000円

セット内訳 数景 価格
MP-1509A(Bベージュ) 1 69,000円
MP-1506A(Bベージュ) 1 57,000円
MP-1509F 1 69,000円
MP-JK15 2 13,000円
MP-FK 2 6,500円
MP-K 2 2,500円 合計価格(税抜き) 288,000円
セット内訳 数景 価格
MP-1512A(ベージュ) 1 69,000円
MP-1509A(ベージュ) 2 63,000円
MP-JK15 2 13,000円
MP-FK 2 6,500円
MP-K 2 2,500円 合計価格(税抜き) 239,000円

セット内訳 数景 価格
MP-1509A(グレー)1 63,000円 MP-1506A(グレー)2 53,000円
MP-JK15 2 13,000円
MP-FK 2 6,500円
MP-K 2 2,500円 合計価格(税抜き) 213,000円
セット内訳 数景 価格
1 68,000円
2 55,000円
2 13,500円
2 6,500円
2 2,500円 合計価格(税抜き) 223,000円
W3000×H1800
MP-1809A(Bグリーン)
MP-1806A(Bグリーン)
MP-JK18
MP-FK
MP-K
三連パネル
W2100×H1800 W2100×H1500 W2400×H1500 W3000×H1500 W2100×H1500
159 SOCIA チェアデスク・収納パーティションテーブルレセプションロビーエクステリアアクセサリー木工 幼保レンタル・リース
VMPシリーズ
抗ウイルス壁紙
パネル表面に抗ウイルス壁紙を採用した 抗ウイルスパーティションです。
45°ピッチで角度の設定が可能。






抗ウイルスパーティ ション 価格(税抜)サイズ(mm)梱包才数梱包重量
VMP-1812A 63,000円 W1200×H1765 ▲ 3.3才11kg
VMP-1809A 55,000円 W900×D1765×H
VMP-1806A 45,000円 W600×D1765×H
▲ 2.5才9.7kg
▲ 1.7才7.8kg
仕様/パネル枠:塩ビ成型品 パネル:フラッシュ合板 抗ウイルスビニ-ル壁紙 パネル厚:30mm 入数:1 ●ピン・マグネットは使用できません。
安定脚


安定脚 価格(税抜) サイズ(mm)
MP-FK 6,500円 W420×H83
MP-F 5,500円 W420×H37
仕様/本体:アルミダイカスト 入数:1 ●ストッパ-付1個、ストッパ-無1個
簡易固定連結樹脂 セット 価格(税抜)


2方向連結


3方向連結


4方向連結








サイズ(mm)
MP-2J 3,000円 上部用:W61×D30×H46.2/下部用:W61×D30×H87.2
MP-3J 4,000円 上部用:W61×D61×H46.2/下部用:W61×D61×H87.2
MP-4J 5,000円 上部用:W83.7×D61×H46.2/下部用:W83.7×D61×H87.2 仕様/本体:樹脂成型品 入数:1 ●角度45°ピッチで設定可能
キャスター脚/アジャスター脚


キャスター脚/アジャスター脚 価格(税抜) サイズ(mm)
MP-K 2,500円 H86
MP-AJ 800円 H35
仕様/本体:樹脂成型品 入数:1 ※パネル1枚のみでのご使用はできません。 ●ストッパ-付
VMP-1812A(IV)
安定脚(キャスター付) MP-FK 安定脚(アジャスター付) MP-F キャスター脚 MP-K アジャスター脚 MP-AJ
VMP-1812A(BL)
VMP-1809A(IV)
VMP-1809A(BL)
VMP-1806A(IV)
VMP-1806A(BL)
上部用 下部用 上部用 下部用 上部用 下部用 MP-2J MP-3J MP-4J IV:アイボリー BL:ブルー
■カラーサンプル
160
MPB.MP.VMPの連結について
キャップをはずすと内側には星形の溝がついており、この溝と連結樹脂についているリブ(45度ピッチ)を かみ合せることによってレイアウトの角度を設定します。
取り付けイメージ
チェアデスク・収納パーティションテーブルレセプションロビーエクステリアアクセサリー木工
パネルをコの字型にレイアウトした中の有効内寸を最大 限に利用したいときは、上記のような組み方にされます と、パネル外寸法通りの内寸が得られます。連結の際は 「連結について」をご覧ください。
パネルモジュール
H1800…立った状態でも視線が遮られる高さ。
H1500…座ると周囲から視線が遮られ、立った状態で見渡せる高さ。
H1200…座った状態でも見渡せる高さ。
H1200 ㎜H1500 ㎜H1800 ㎜
2方向(直線)連結
パーツ 数量
①パネル本体 3枚
②安定脚(アジャスター付) 3本 ③アジャスター脚 1個
④簡易固定連結樹脂(2方向) 2set
コの字型連結
パーツ 数量
①パネル本体 7枚
②安定脚(アジャスター付) 3本 ③アジャスター脚 5個
④簡易固定連結樹脂(2方向) 6set
4方向(十字)連結
パーツ 数量
①パネル本体 8枚 ②安定脚(アジャスター付) 4本 ③アジャスター脚 4個
④簡易固定連結樹脂(2方向) 4set
⑤簡易固定連結樹脂(4方向) 1set
2方向連結の際、連結樹脂のアジャスターがついてい ない側のパネルエンドに、アジャスター脚をセットされます と、より安定したセッティングが可能です。
パネル1枚[安定脚(アジャスター付)]
パーツ 数量 ①パネル本体 1枚 ②安定脚(アジャスター付) 2本 パーツ 数量 ①パネル本体 1枚 ②安定脚(キャスター付) 2本 パーツ 数量 ①パネル本体 5枚 ②安定脚(アジャスター付) 3本 ③アジャスター脚 3個 ④簡易固定連結樹脂(2方向) 4set
パネル1枚[安定脚(キャスター付)] 2方向(L字)連結
3方向(T字)連結
パーツ 数量 ①パネル本体 5枚 ②安定脚(アジャスター付) 2本 ③アジャスター脚 3個 ④簡易固定連結樹脂(2方向) 2set ④簡易固定連結樹脂(3方向) 1set
可動連結セット例
パーツ 数量 ①パネル本体 1枚 ②パネル本体 1枚 ③安定脚(キャスター付) 2本 ④キャス ター脚 1個 ⑤可動連結セット(2方向) 1set
設置上の注意 安心してご使用いただくために下記の点にご注意ください。
・直線で設置する場合
・�直線連結の長さは、3600mmまでにして ください。
MPシリーズ MPシリーズ MPシリーズ
・�両端及びパネル2枚ごとに両側安定脚を 1本取り付けてください。
※パネルを1枚だけで使用する場合、 両端に安定脚が必要です。
・L字型に設置する場合
・長い辺ⓐは3600mmまでにしてください。 ・短い辺ⓑが1200mm未満の場合、 コーナー外側に安定脚を1本取り付けてください。 ・連結パネルが2枚以上になる場合、 両端及びパネル2枚ごとに安定脚を 1本取り付けてください。
・コの字型に設置する場合
・長い辺ⓐは3600mmまでにしてください。
幼保レンタル・リース
・短い辺ⓑが1200mm未満の場合、 コーナー外側に安定脚を1本取り付けてください。
・連結パネルが2枚以上になる場合、 両端及びパネル2枚ごとに安定脚を 1本取り付けてください。
MPシリーズ 取り付けイメージ 2方向 4方向 支柱内部 3方向 T字型 Y字型 180° 135° 90° 45° 90° 35°1 90° 取り付けイメージ 2方向 4方向 支柱内部 3方向 T字型 Y字型 180° 135° 90° 45° 90° 135° 取り付けイメージ 2方向 4方向 支柱内部 3方向 T字型 Y字型 180° 135° 90° 45° 90° 135° 取り付けイメージ 2方向 4方向 支柱内部 3方向 T字型 Y字型 180° 135° 90° 45° 90° 135° 取り付けイメージ 2方向 4方向 支柱内部 3方向 T字型 Y字型 180° 135° 90° 45° 90° 135° 取り付けイメージ 2方向 4方向 支柱内部 3方向 T字型 Y字型 180° 135° 90° 45° 90° 135° 2方向 4方向 支柱内部 3方向 T字型 Y字型 180° 135° 90° 45° 90° 135° 2方向 4方向 支柱内部 3方向 T字型 Y字型 180° 135° 90° 45° 90° 135° 2方向 4方向 支柱内部 3方向 T字型 Y字型 180° 135° 90° 45° 90° 135° W1200 パネルW1200 W1200 パネルW1200 600 700 800 900 1200
支柱内部
3方向 4方向
2方向
161 SOCIA
抗ウイルスパーティション

AP-Vパネル

パネル面に付着したウイルスを激減させる 特殊なパネルを採用したパーティション。




 脇机 LDC-WD3(WH) P.137
チェア CK01(BK) P.079 デスク LDC-H127(WH) P.137
チェア HP-330LG(PK) P.094
AP-1509V(PK)、PSA-FK×2
脇机 LDC-WD3(WH) P.137
チェア CK01(BK) P.079 デスク LDC-H127(WH) P.137
チェア HP-330LG(PK) P.094
AP-1509V(PK)、PSA-FK×2
WH:ホワイト PK:ピンク GN:グリーン NA:ナチュラル BR:ブラウン ■カラーサンプル 162
AP-Vシリーズ
H1800mm
チェアデスク・収納パーティションテーブルレセプションロビーエクステリアアクセサリー木工

AP-1812V(GN)



H1500mm


抗ウイルスパーティ ション 価格(税抜)サイズ(mm)梱包才数梱包重量
AP-1512V
AP-1507V 89,000円 W700×D25×H1500
仕様/パネル:ペ-パ-ハニカム 表面抗ウイルスメラミン化粧板 フレ-ム:アルミ押出成型品 アルマイト仕上げ パネル厚:18mm 入数:1
H1200mm


抗ウイルスパーティ ション 価格(税抜)サイズ(mm)梱包才数梱包重量
AP-1212V 85,900円 W1200×D25×H1200 ▲ 2.2才12.5kg
AP-1210V 83,800円 W1000×D25×H1200 ▲ 2.1才11.8kg
AP-1209V 79,700円 W900×D25×H1200 ▲ 1.7才10kg
AP-1207V 73,500円 W700×D25×H12001.6才9.3kg 仕様/パネル:ペ-パ-ハニカム 表面抗ウイルスメラミン化粧板 フレ-ム:アルミ押出成型品 アルマイト仕上げ パネル厚:18mm 入数:1
安定脚(キャスタータイプ) 安定脚(両脚タイプ)

安定脚 (キャスタータイプ)
AP-1809V+PSA-FK×2


幼保レンタル・リース

円
円
1500 1800 1200 抗ウイルスパーティ ション 価格(税抜)サイズ(mm)梱包才数梱包重量 AP-1812V 111,800円 W1200×D25×H1800 ▲ 3.3才 17.4kg AP-1810V 109,700円 W1000×D25×H1800 ▲ 3.2才 15kg AP-1809V 101,600円 W900×D25×H1800 ▲ 2.5才 14.4kg 仕様/パネル:ペ-パ-ハニカム 表面抗ウイルスメラミン化粧板 フレ-ム:アルミ押出成型品 アルマイト仕上げ パネル厚:18mm 入数:1
101,400円 W1200×D25×H1500 ▲ 2.7才15.5kg
99,400円 W1000×D25×H1500 ▲ 2.6才14.7kg
91,100円 W900×D25×H1500 ▲ 2.1才11.9kg
AP-1510V
AP-1509V
▲
2.0才11kg
安定脚 (両脚タイプ) 価格(税抜) AP-1512V+PSA-RF×2 110,800円 AP-1509V+PSA-RF×2 100,500円
価格(税抜) AP-1812V+PSA-FK×2 122,000
111,800
AP-1512V(PK)
AP-1812V(NA)+PSA-FK×2
AP-1809V(BR)+PSA-FK×2
AP-1512V(WH)+PSA-RF×2
AP-1509V(GN)+PSA-RF×2
AP-1510V(WH)
AP-1209V(NA)
AP-1207V(BR)
AP-1810V(WH)
AP-1809V(BR)
163 SOCIA
AP-1809V(NA)











 PSB-1512A(PIV)
PSB-1507A(PIV)
ロビー RO-S1200(FBJ) P.256 SOCIA ASO-DT-1290B(MAK) P.044
PSB-1512A(PIV)
PSB-1507A(PIV)
ロビー RO-S1200(FBJ) P.256 SOCIA ASO-DT-1290B(MAK) P.044
PSA/PSBシリーズ
チェア EL-6W-ZR-BK P.101
PSA-RF
PSA-1509F
PSA-1512F
床面からパネルまでの高さは30mmです。 パネル部(半透明) ポリカーボネイト PIV アイボリー PGN グリーン PBL ブルー PBJ ベージュ ■カラーサンプル(合成皮革) グレー ベージュ オレンジ グリーン ブルー ■カラーサンプル(防炎加工布) 164
PSA-RF


PSBパネル H1800mm H1500mm



アルミパーティション 価格(税抜)サイズ(mm)梱包才数梱包重量
PSB-1812A 79,000円 W1200×D25×H1800 ▲ 3.3才12.4kg
PSB-1810A 77,000円 W1000×D25×H1800 ▲ 3.2才12.2kg
PSB-1809A 72,000円 W900×D25×H1800 ▲ 2.5才9.6kg
仕様/パネル:ペ-パ-ハニカム 表面布張り・パネル:ペ-パ-ハニカム 表面PVC張り フレ-ム:アルミ押出成型品 アルマイト仕上げ パネル厚:18mm 入数:1




アルミパーティション 価格(税抜)サイズ(mm)梱包才数梱包重量
PSB-1512A 67,000円 W1200×D25×H1500 ▲ 2.7才10.2kg
PSB-1510A 64,000円 W1000×D25×H15002.6才10kg
PSB-1509A 60,000円 W900×D25×H15002.1才7.9kg
PSB-1507A 57,000円 W700×D25×H15002.0才7.7kg
仕様/パネル:ペ-パ-ハニカム 表面布張り・パネル:ペ-パ-ハニカム 表面PVC張り
フレ-ム:アルミ押出成型品 アルマイト仕上げ パネル厚:18mm 入数:1
ポリカーボネイト H1500mm H1200mm


アルミパーティション 価格(税抜)サイズ(mm)梱包才数梱包重量 PSB-1212A
PSB-1209A
円 W900×D25×H12001.7才6.8kg
PSB-1207A 48,300円 W700×D25×H12001.6才6.6kg 仕様/パネル:ペ-パ-ハニカム 表面布張り・パネル:ペ-パ-ハニカム 表面PVC張り フレ-ム:アルミ押出成型品 アルマイト仕上げ パネル厚:18mm 入数:1
キャスター脚





ポリカーボネイト

全面透明パネル 価格(税抜)サイズ(mm)梱包才数梱包重量
PSB-1512F 90,000円 W1200×D25×H1500 ▲ 2.7才10.2kg
PSB-1509F 71,000円 W900×D25×H15002.1才6kg
仕様/フレ-ム:アルミ押出成型品 アルマイト仕上げ パネル透明部:ポリカ-ボネイト (t6 mm) 入数:1
安定脚


幼保レンタル・リース

59,000円 W1200×D25×H12002.2才8.3kg
56,000円 W1000×D25×H12002.1才8.1kg
PSB-1210A
53,000
PSB-1812A(PBL) PSB-1810A(PGN)
PSB-1809A(PIV) PSB-1512A(PBJ) PSB-1510A(PBL) PSB-1509A(PGN)
PSB-1212A(ブルー) PSB-1209A(オレンジ)
PSB-1209A(グレー)
PSB-1512F
PSB-1509F パネル部(半透明)
PSB-1812A(ベージュ) +PSB-FK×2
89,200円(税抜)
PSB-1509A(グレー) +PSB-FK×2 70,200円(税抜)
PSB-1207A(ブルー) +PSB-FK×2 58,500円(税抜)
PSB-1812A(オレンジ) +PSB-RF×2 88,400円(税抜)
PSB-1509A(グリーン) +PSB-RF×2 69,400円(税抜)
165 SOCIA チェアデスク・収納パーティションテーブルレセプションロビーエクステリアアクセサリー木工
PSB-1207A(ベージュ) +PSB-RF×2 57,700円(税抜)

2方向連結(直線)(PSB-2J×1)

連結支柱

連結に際しての注意
・直線及びL字連結には連結金具PSA-2Jをご使用ください。



2方向連結(L字)(PSB-2J×1)3方向連結(PSB-JK18PSB-MJ×3)4方向連結(PSB-JK18×1PSB-MJ×4)
高さ違い連結(PSB-JK18×1PSB-MJ×4)
連結金具 (2方向用) 価格(税抜)サイズ(mm)梱包才数梱包重量
PSB-2J 1,800円 W50×D25×t50.02才 0.1kg 仕様/本体:アルミ アルマイト仕上げ 入数:1セット((上・下2個入) 個口)
連結金具 (3方向・4方向用) 価格(税抜)サイズ(mm)梱包才数梱包重量
PSB-MJ 1,400円 W33×D25×t50.01才 0.1kg
仕様/本体:アルミ アルマイト仕上げ 入数:1セット((上・下2個入) 個口)
連結支柱 価格(税抜)サイズ(mm)梱包才数梱包重量
PSB-JK18 11,700円 W25×D25×H18000.1才 1.2kg
PSB-JK15 10,300円 W25×D25×H15000.1才 0.9kg
PSB-JK12 9,100円 W25×D25×H12000.04才 0.8kg
仕様/本体:アルミ押出成型品 アルマイト仕上げ 入数:1
連結イメージ PSA-2J(上部) (下部) PSA-MJ(上部)(上部)
・�3方向及び4方向連結には連結支柱PSA-JKシリーズ、連結金具PSA-MJが必要になります。
また2方向連結(直線・L字)にも連結支柱を入れる事が可能です。その際、パネル設置後 の内寸が変化しますのでご注意ください。
※高さ違いの場合は連結支柱PSA-JKシリーズ、連結金具PSA-MJが必要になります。
・安定脚PSA-Fは、パネル連結時の中間用や、パネル端部にご使用いただけます。
・単体でご使用される際には、安定脚PSA-Fを4つ、もしくはPSA-RFを2つご使用ください。
・安定脚タイプとキャスタータイプの連結はできません。
・連結部は可動しないので無理に可動させると破損や事故につながる可能性がございます。
・キャスター脚仕様でのご使用の場合、連結金具は使用できませんのでご注意ください。








安定脚 価格(税抜)サイズ(mm)梱包才数梱包重量
TPA-RF 4,700円 W32×D400×H1620.1才1.1kg
仕様/本体:スチ-ル 粉体塗装 (ブラック) 入数:1
キャスター脚 価格(税抜)サイズ(mm)梱包才数梱包重量
TPA-FK 5,100円 W32×D400×H1850.1才1.1kg
仕様/本体:スチ-ル 粉体塗装 (ブラック) キャスタ-:樹脂成型品 (ストッパ-付1個、ストッパ-無1個)
入数:1 ●キャスタ-仕様の場合、パネル高が40mm高くなります。
パンフレット ケース 価格(税抜)サイズ(mm)梱包才数梱包重量 PCP-102 16,000円 W235×D120×H7700.4才 2kg 仕様/本体:スチ-ル 粉体塗装 (シルバ-) ケ-ス:樹脂成型品 入数:1 ●付属のサイズチェンジパ-ツ を使えば、A4以下 (DM・A5・A6・B5・B6・ハガキ) が収納可能です。 ●パ-ティションフック可動域:25~ 55mmまで調整可能です。
連結パーツ
(PSB-JK18 PSB-JK15)
PCP-102(GR) (パンフレットケース)
サイズチェンジパーツで A4以下の収納が可能です。
166
PSAパネル H1800mm H1500mm



▲ 3.2才12.2kg
PSA-1809A 72,000円 W900×D25×H1800 ▲ 2.5才9.6kg
仕様/パネル:ペ-パ-ハニカム 表面布張り・パネル:ペ-パ-ハニカム 表面PVC張り フレ-ム:アルミ押出 成型品 アルマイト仕上げ パネル厚:18mm 入数:1



アルミパーティション 価格(税抜)サイズ(mm)梱包才数梱包重量
PSA-1512A 67,000円 W1200×D25×H1500 ▲ 2.7才10.2kg
PSA-1510A 64,000円 W1000×D25×H15002.6才10kg
PSA-1509A 60,000円 W900×D25×H15002.1才7.9kg
PSA-1507A 57,000円 W700×D25×H15002.0才7.7kg
仕様/パネル:ペ-パ-ハニカム 表面布張り・パネル:ペ-パ-ハニカム 表面PVC張り フレ-ム:アルミ押出 成型品 アルマイト仕上げ パネル厚:18mm 入数:1
ポリカーボネイト H1500mm H1200mm



アルミパーティション 価格(税抜)サイズ(mm)梱包才数梱包重量
PSA-1212A 59,000円 W1200×D25×H12002.2才8.3kg
PSA-1210A 56,000円 W1000×D25×H12002.1才8.1kg
PSA-1209A 53,000円 W900×D25×H12001.7才6.8kg
PSA-1207A 48,300円 W700×D25×H12001.6才6.6kg 仕様/パネル:ペ-パ-ハニカム 表面布張り・パネル:ペ-パ-ハニカム 表面PVC張り フレ-ム:アルミ押出 成型品 アルマイト仕上げ パネル厚:18mm 入数:1
キャスター脚





ポリカーボネイト

全面透明パネル 価格(税抜)サイズ(mm)梱包才数梱包重量
PSA-1512F 90,000円 W1200×D25×H1500 ▲ 2.7才10.2kg
PSA-1509F 71,000円 W900×D25×H15002.1才6kg
仕様/フレ-ム:アルミ押出成型品 アルマイト仕上げ パネル透明部:ポリカ-ボネイト (t6mm) 入数:1
安定脚


幼保レンタル・リース

アルミパーティション 価格(税抜)サイズ(mm)梱包才数梱包重量 PSA-1812A 79,000円 W1200×D25×H1800 ▲ 3.3才12.4kg PSA-1810A 77,000円 W1000×D25×H1800
PSA-1812A(PBL) PSA-1810A(PGN)
PSA-1809A(PIV) PSA-1512A(PBJ) PSA-1510A(PBL) PSA-1509A(PGN)
PSA-1212A(ブルー) PSA-1209A(オレンジ)
PSA-1209A(グレー)
PSA-1512F
PSA-1509F パネル部(半透明)
PSA-1812A(ベージュ) +PSA-FK×2 89,200円(税抜)
PSA-1509A(グレー) +PSA-FK×2 70,200円(税抜)
PSA-1207A(ブルー) +PSA-FK×2 58,500円(税抜)
PSA-1812A(オレンジ) +PSA-RF×2 88,400円(税抜)
PSA-1509A(グリーン) +PSA-RF×2 69,400円(税抜)
167 SOCIA チェアデスク・収納パーティションテーブルレセプションロビーエクステリアアクセサリー木工
PSA-1207A(ベージュ) +PSA-RF×2 57,700円(税抜)
オプションパーツ

2方向連結(直線) (PSA-2J×1)

※フレームは「PSAシリーズ」と共通のため、連結パーツや安定脚などのオプションパーツが ご利用いただけます。



2方向連結(L字) (PSA-2J×1)
3方向連結(PSA-JK18 PSA-MJ×3)
連結金具 (2方向用) 価格(税抜)サイズ(mm)梱包才数梱包重量
PSA-2J 1,800円 W50×D25×t50.02才0.1kg
仕様/本体:アルミ アルマイト仕上げ 入数:1セット(上・下2個入)

連結支柱 (PSA-JK18 PSA-JK15)
連結支柱 価格(税抜)サイズ(mm)梱包才数梱包重量
PSA-JK18
PSA-JK15
11,700円 W25×D25×H18000.1才1.2kg
10,300円 W25×D25×H15000.1才0.9kg
PSA-JK12 9,100円 W25×D25×H12000.04才0.8kg
仕様/本体:アルミ押出成型品 アルマイト仕上げ 入数:1

安定脚(両脚タイプ)(PSA-RF×1)
安定脚 (両脚タイプ) 価格(税抜)サイズ(mm)梱包才数梱包重量
PSA-RF 4,700円 W32×D400×H1620.1才1.1kg
仕様/本体:スチ-ル 粉体塗装 (シルバ-) 入数:1
! 連結に際しての注意
4方向連結(PSA-JK18×1 PSA-MJ×4)
高さ違い連結(PSA-JK18×1 PSA-MJ×4)
連結金具 (3方向・4方向用) 価格(税抜)サイズ(mm)梱包才数梱包重量
PSA-MJ 1,400円 W33×D25×t50.01才0.1kg
仕様/本体:アルミ アルマイト仕上げ 入数:1セット(上・下2個入)

安定脚(片脚タイプ)(PSA-F×1)
安定脚 (片脚タイプ) 価格(税抜)サイズ(mm)梱包才数梱包重量
PSA-F 3,300円 W27×D190×H1500.1才0.6kg
仕様/本体:スチ-ル 粉体塗装 (シルバ-) 入数:1

安定脚(キャスタータイプ)(PSA-FK×1)
安定脚 (キャスター脚タイプ) 価格(税抜)サイズ(mm)梱包才数梱包重量 PSA-FK 5,100円 W32×D400×H1850.1才1.1kg 仕様/本体:スチ-ル 粉体塗装 (シルバ-) キャスタ-:樹脂成型品 (ストッパ-付1個、ストッパ-無1個) 入数:1 ●キャスタ-仕様の場合、パネル高が40mm高くなります。
・直線及びL字連結には連結金具PSA-2Jをご使用ください。
・3方向及び4方向連結には連結支柱PSA-JKシリーズ、連結金具PSA-MJが必要になります。
また2方向連結(直線・L字)にも連結支柱を入れる事が可能です。その際、パネル設置後の内寸が変化します のでご注意ください。
※高さ違いの場合は連結支柱PSA-JKシリーズ、連結金具PSA-MJが必要になります。
・安定脚PSA-Fは、パネル連結時の中間用や、パネル端部にご使用いただけます。
・単体でご使用される際には、安定脚PSA-Fを4つ、もしくはPSA-RFを2つご使用ください。
・安定脚タイプとキャスタータイプの連結はできません。
・連結部は可動しないので無理に可動させると破損や事故につながる可能性がございます。
・キャスター脚仕様でのご使用の場合、連結金具は使用できませんのでご注意ください。
連結イメージ
PSA-2J(上部)(下部)


PSA-MJ(上部)(上部)


168
PSB、PSA、APの連結について
パネルモジュール
H1800…立った状態でも視線が遮られる高さ。
H1500…座ると周囲から視線が遮られ、立った状態で見渡せる高さ。
チェアデスク・収納パーティションテーブルレセプションロビーエクステリアアクセサリー木工
H1200…座った状態でも見渡せる高さ。
H1200 ㎜H1500 ㎜H1800 ㎜
2方向(直線)連結 パーツ 数量 ①パネル本体3枚 ②安定脚(両脚タイプ)3本 ③安定脚(片脚タイプ)1個 ④連結パーツ(2方向連結)2set
コの字型連結
パネル1枚[安定脚(両脚タイプ)] パーツ 数量 ①パネル本体1枚 ②安定脚(両脚タイプ)2本
パネル1枚[安定脚(キャスター脚タイプ)]
パーツ 数量 ①パネル本体1枚 ②安定脚(キャスター脚タイプ)2本
2方向(L字)連結
パーツ 数量 ①パネル本体5枚 ②安定脚(両脚タイプ2本 ③安定脚(片脚タイプ1本 ④連結パーツ(2方向用)4set
十字連結 パーツ 数量 ①パネル本体8枚 ②安定脚(両脚タイプ)4本 ③連結パーツ(2方向用)4set ④連結パーツ(3方向・4方向用)4set ⑤連結支柱1本
高さ違い連結1
高さ違い連結2 パーツ 数量 ①パネル本体7枚 ②安定脚(両脚タイプ)2本 ③安定脚(片脚タイプ)1本 ④連結パーツ(2方向用)6set パーツ 数量 ①パネル本体1枚 ②パネル本体1枚 ③安定脚(両脚タイプ)2本 ④連結パーツ(3方向・4方向用)2set ⑤連結支柱1本
パーツ 数量 ①パネル本体2枚 ②パネル本体2枚 ③安定脚(両脚タイプ)2本 ④連結パーツ(2方向用)2set ⑤連結パーツ(3方向・4方向用)2set ⑥連結支柱1本
設置上の注意 安心してご使用いただくために下記の点にご注意ください。
・直線で設置する場合
・直線連結の長さは、3600mmまでにして ください。
PSAシリーズPSAシリーズPSAシリーズ
両端及びパネル2枚ごとに安定脚を 1本取り付けてください。
※パネルを1枚だけで使用する場合、 両端に安定脚が必要です。
・L字型に設置する場合
・長い辺ⓐは3600mmまでにしてください。 ・短い辺ⓑが1200mm未満の場合、 コーナー外側に安定脚を1本取り付けて ください。
・連結パネルが2枚以上になる場合、 両端及びパネル2枚ごとに安定脚を 1本取り付けてください。
・コの字型に設置する場合 ・長い辺ⓐは3600mmまでにしてください。 ・短い辺ⓑが1200mm未満の場合、 コーナー外側に安定脚を1本取り付けて ください。
・連結パネルが2枚以上になる場合、 両端及びパネル2枚ごとに安定脚を 1本取り付けてください。
幼保レンタル・リース
1000 1200
169 SOCIA

システムパーティション

マグネット式のシステムパネルで簡単に連結・設置が可能。
パネル面の交換が工具不要で簡単に行えます。














WH:ホワイト NA:ナチュラル MAK:ミディアムオーク DBR:ダークブラウン BR:ブラウン ■カラーサンプル 抗ウイルス IV:アイボリー WT:ウォールナット NA:ナチュラル BR:ブラウン ポリ OR:オレンジ GR:グレイ GN:グリーン BL:ブルー BJ:ベージュ 防炎布 170
ドアパネル H2100
チェアデスク・収納パーティションテーブルレセプションロビーエクステリアアクセサリー木工



パネル H2100



システムパーティション

KPZ-DR2109P(WT/NA/BR)
KPZ-DR2109P(IV)
KPZ-DL2109V
KPZ-DR2109V 409,000円 W900×D35×H2100
16.1才15kg
仕様/パネル枠:アルミ パネル:F/布、P/ポリエステル化粧板、V/抗ウイルスメラミン化粧板 入数:1 ※品番の「DL」は左開き、「DR」は右開きです。 ※ドアパネルはパネル交換できません。


KPZ説明(鍵・外側)KPZ説明(鍵・内側)
H1800



KPZ-1806F 69,000円 W600×D35×H18002.3才8.5kg
KPZ-1806P(BR/NA/WT)
KPZ-1806P(IV)
KPZ-1806V 91,000円 W600×D35×H18002.3才8.5kg
仕様/パネル枠:アルミ パネル:F/布、P/ポリエステル化粧板、V/抗ウイルスメラミン化粧板 入数:1


価格(税抜)サイズ(mm)梱包才数梱包重量
KPZ-2112F 111,000円 W1200×D35×H2100 ▲ 5.3才17.1kg
KPZ-2112P(BR/NA/WT) 135,000円 W1200×D35×H2100 ▲ 5.3才17.1kg
KPZ-2112P(IV) 103,000円 W1200×D35×H2100 ▲ 5.3才17.1kg
KPZ-2112V 147,000円 W1200×D35×H2100 ▲ 5.3才17.1kg
KPZ-2109F 101,000円 W900×D35×H2100 ▲ 4.0才13.4kg
KPZ-2109P(BR/NA/WT) 110,000円 W900×D35×H2100 ▲ 4.0才13.4kg
KPZ-2109P(IV) 97,000円 W900×D35×H2100 ▲ 4.0才13.4kg
KPZ-2109V 137,000円 W900×D35×H2100 ▲ 4.0才13.4kg
KPZ-2106F 80,000円 W600×D35×H2100 ▲ 2.7才9.6kg
KPZ-2106P(BR/NA/WT) 92,000円 W600×D35×H2100 ▲ 2.7才9.6kg
KPZ-2106P(IV) 76,000円 W600×D35×H2100 ▲ 2.7才9.6kg
KPZ-2106V 99,000円 W600×D35×H2100 ▲ 2.7才9.6kg
仕様/パネル枠:アルミ パネル:F/布、P/ポリエステル化粧板、V/抗ウイルスメラミン化粧板 入数:1
H1500



システムパーティション 価格(税抜)サイズ(mm)梱包才数梱包重量
KPZ-1512F 89,000円 W1200×D35×H1500 ▲ 3.8才12.8kg
KPZ-1512P(BR/NA/WT) 126,000円 W1200×D35×H1500 ▲ 3.8才12.8kg
KPZ-1512P(IV) 93,000円 W1200×D35×H1500 ▲ 3.8才12.8kg
KPZ-1512V 135,000円 W1200×D35×H1500 ▲ 3.8才12.8kg
KPZ-1509F 84,000円 W900×D35×H15002.8才10.1kg
KPZ-1509P(BR/NA/WT) 91,000円 W900×D35×H15002.8才10.1kg
KPZ-1509P(IV) 75,000円 W900×D35×H15002.8才10.1kg
KPZ-1509V 103,000円 W900×D35×H15002.8才10.1kg
KPZ-1506F 65,000円 W600×D35×H15001.9才7.4kg
幼保レンタル・リース
KPZ-1506P(BR/NA/WT) 82,000円 W600×D35×H15001.9才7.4kg
KPZ-1506P(IV) 66,000円 W600×D35×H15001.9才7.4kg
KPZ-1506V 87,000円 W600×D35×H15001.9才7.4kg
仕様/パネル枠:アルミ パネル:F/布、P/ポリエステル化粧板、V/抗ウイルスメラミン化粧板 入数:1


システムパーティション 価格(税抜)サイズ(mm)梱包才数梱包重量 KPZ-1812F 100,000円 W1200×D35×H1800 ▲ 4.5才15kg
129,000円 W1200×D35×H1800 ▲ 4.5才15kg KPZ-1812P(IV) 97,000円 W1200×D35×H1800 ▲ 4.5才15kg KPZ-1812V 138,000円 W1200×D35×H1800 ▲ 4.5才15kg
89,000円 W900×D35×H1800 ▲ 3.4才11.9kg
94,000円 W900×D35×H1800 ▲ 3.4才11.9kg
79,000円 W900×D35×H1800 ▲ 3.4才11.9kg
108,000円 W900×D35×H1800 ▲ 3.4才11.9kg
KPZ-1812P(BR/NA/WT)
KPZ-1809F
KPZ-1809P(BR/NA/WT)
KPZ-1809P(IV)
KPZ-1809V
85,000円 W600×D35×H18002.3才8.5kg
77,000
円 W600×D35×H18002.3才8.5kg
システムパーティション 価格(税抜)サイズ(mm)梱包才数梱包重量 KPZ-DL2109F 304,000円 W900×D35×H2100 ▲ 16.1才15kg KPZ-DR2109F 304,000円 W900×D35×H2100 ▲ 16.1才15kg KPZ-DL2109P(BR/NA/WT) 367,000円 W900×D35×H2100 ▲ 16.1才15kg KPZ-DL2109P(IV) 220,000円 W900×D35×H2100 ▲ 16.1才15kg
円 W900×D35×H2100 ▲ 16.1才15kg
367,000
220,000円 W900×D35×H2100 ▲ 16.1才15kg
409,000円 W900×D35×H2100 ▲ 16.1才15kg
▲
抗ウイルス 抗ウイルス ポリ化粧板 ポリ化粧板 ポリ化粧板 ポリ化粧板 防炎布 防炎布 防炎布 防炎布
抗ウイルス 抗ウイルス
KPZ-DR2109V(NA)KPZ-DL2109P(IV)KPZ-DL2109F(BJ)KPZ-2112V(BR)KPZ-2109P(NA)KPZ-2106F(GR)
KPZ説明(直線連結) KPZ説明(L型連結) KPZ説明(3方向連結) KPZ説明(4方向連結) 171 SOCIA
KPZ-1812P(WT)KPZ-1809P(IV)KPZ-1806F(GN)KPZ-1512V(DBR)KPZ-1509P(WT)KPZ-1506F(OR)
KPZパーティション
連結支柱

ベースなし
L型連結支柱
3方向連結支柱
4方向連結支柱
KPZ-JK21SJKPZ-JK21LJKPZ-JK213JKPZ-JK214J

ベース付き
直線連結支柱 価格(税抜)サイズ(mm)梱包才数梱包重量
KPZ-JK21SJ 3,500円 W19×D19×H21000.1才1.3kg
KPZ-JK18SJ 3,400円 W19×D19×H18000.1才1.1kg
KPZ-JK15SJ 3,300円 W19×D19×H15000.1才0.9kg
仕様/本体:スチ-ル クロ-ムメッキ 入数:1
3方向連結支柱 価格(税抜)サイズ(mm)梱包才数梱包重量
KPZ-JK213J 21,700円 W75×D75×H21000.7才5.5kg
KPZ-JK183J 21,300円 W75×D75×H18000.6才4.7kg
KPZ-JK153J 21,300円 W75×D75×H15000.5才3.9kg
仕様/本体:スチ-ル クロ-ムメッキ 入数:1
上部ストッパー 直線連結支柱 直線ストッパー

※直線連結支柱単体では使用できません。 ベースと合わせて使用してください。 ※L型連結支柱、3方向連結支柱、4方向連結支 柱にはあらかじめベースが取り付けてありますので ベースは必要ありません
L型連結支柱 価格(税抜)サイズ(mm)梱包才数梱包重量
KPZ-JK21LJ 17,500円 W75×D75×H21000.7才4.2kg
KPZ-JK18LJ 17,400円 W75×D75×H18000.6才3.6kg
KPZ-JK15LJ 17,300円 W75×D75×H15000.5才3kg
仕様/本体:スチ-ル クロ-ムメッキ 入数:1
4方向連結支柱 価格(税抜)サイズ(mm)梱包才数梱包重量
KPZ-JK214J 29,700円 W75×D75×H21000.7才6.8kg
KPZ-JK184J 29,300円 W75×D75×H18000.6才5.8kg
KPZ-JK154J 29,300円 W75×D75×H15000.5才4.8kg
仕様/本体:スチ-ル クロ-ムメッキ 入数:1
L型ストッパー

4方向ストッパー エンドストッパー


3方向ストッパー


エンドストッパー単体
3方向ストッパー/ L型ストッパー/直線ストッパー 価格(税抜)サイズ(mm)梱包才数梱包重量
KPZ-H3 5,700円 W158×D85×H1000.1才0.2kg
KPZ-HL 5,600円 W95×D95×H1000.1才0.2kg
KPZ-HS 4,200円 W120×D32×H1000.1才0.2kg
仕様/本体:スチ-ル クロ-ムメッキ 入数:1 転倒防止のため必ずストッパ-を取り付けてください。
4方向ストッパー/ エンドストッパー 価格(税抜)サイズ(mm)梱包才数梱包重量
KPZ-H4 7,700円 W158×D158×H1000.2才0.3kg
KPZ-HE 4,700円 W74×D32×H1000.1才0.1kg
仕様/本体:スチ-ル クロ-ムメッキ 入数:1 転倒防止のため必ずストッパ-を取り付けてください。
※ストッパーの取り付けには連結支柱が必要です。
エンドストッパーにも直線連結支柱が必要です。
KPZ-HSKPZ-HLKPZ-H3
KPZ-H4KPZ-HE
172
カバー L型カバー 3方向カバー
チェアデスク・収納パーティションテーブルレセプションロビーエクステリアアクセサリー木工


エンドカバー

KPZ-EC21LJKPZ-EC213JKPZ-EC21SJ
L型エンドカバー 価格(税抜)サイズ(mm)梱包才数梱包重量
KPZ-EC21LJ 12,800円 W37×D37×H21000.1才0.6kg
KPZ-EC18LJ 11,800円 W37×D37×H18000.1才0.5kg
KPZ-EC15LJ 11,300円 W37×D37×H15000.1才0.5kg
仕様/本体:アルミ 入数:1
エンドカバー 価格(税抜)サイズ(mm)梱包才数梱包重量
KPZ-EC21SJ 12,800円 W35×D15×H21000.2才0.8kg
KPZ-EC18SJ 11,800円 W35×D15×H18000.2才0.7kg
KPZ-EC15SJ 11,300円 W35×D15×H15000.1才0.6kg
仕様/本体:アルミ 入数:1
※直線連結、4方向連結にはカバーは取り付けできません。
3方向エンドカバー 価格(税抜)サイズ(mm)梱包才数梱包重量
KPZ-EC213J 12,000円 W38×D5×H21000.3才0.5kg
KPZ-EC183J 11,400円 W38×D5×H18000.2才0.4kg
KPZ-EC153J 11,000円 W38×D5×H15000.2才0.4kg
仕様/本体:アルミ 入数:1
ベース

エンド用ベース 両面用ベース


エンドカバーを取り付けた状態

エンドカバーを取り付けた状態


ベース 価格(税抜)サイズ(mm)梱包才数梱包重量
KPZ-B75 9,400円 W75×D75×H2450.1才0.3kg
KPZ-B100 16,000円 W100×D500×H2450.6才1.9kg
仕様/本体:スチ-ル クロ-ムメッキ 入数:1
丸ベース

75角ベース

※ベース単体では使用できません。 直線連結支柱と合わせて使用してください。
ベース 価格(税抜)サイズ(mm)梱包才数梱包重量
KPZ-BE 17,000円 W100×D350×H2450.6才1.9kg
KPZ-BR 18,400円 φ380×H2451.6才4kg 仕様/本体:スチ-ル クロ-ムメッキ 入数:1
幼保レンタル・リース
KPZ-BE
KPZ-B75
KPZ-B100
KPZ-BR
173 SOCIA
設置上の注意
安心してご使用いただくために下記の点にご注意ください。
・連結支柱について
・パネルを1枚だけで使用する場合は、両端に直線連結支柱を使用してください。
・2枚以上連結させる場合は、設置場所に応じて直接連結支柱、L型連結支柱、3方向連結支柱、4方向連結支柱のい ずれかを使用してください。端には直線連結支柱が必要になります。
※直線連結支柱単体では使用できません。 必ず両面用ベース、エンドベース、丸ベース、75角ベースのいずれかを使用し てください。
※L型連結支柱、3方向連結支柱、4方向連結支柱にはあらかじめベースが取り付けてありますのでベースは必要ありません。
・上部ストッパーについて
・2枚以上連結させる場合は、連結支柱に合わせて直線ストッパー、L型ストッパー、3方向ストッパー4方向ストッパーのい ずれかを必ず使用してください。また、外端には必ず直線連結支柱とエンドストッパーを使用してください。
・パネルを1枚だけで使用する場合は、両端に直線連結支柱とエンドストッパーを必ず使用してください。
・カバーについて
・パネルを1枚だけで使用する場合は、両端にエンドカバーを使用してください。
・2枚以上連結させる場合は、設置場所に応じてL型エンドカバー、3方向エンドカバーのいずれかを使用して下さい。また外 端にはエンドカバーを使用してください。
※カバー単体では使用できません。必ず直線連結支柱、L型連結支柱、3方向連結支柱と合わせて使用してください。
・ベースについて
・直線連結支柱を使用する場合は、設置場所に応じて両面用ベース、エンドベース、丸ベース、75角ベースのいずれかを 使用してください。
・パネルを壁際に設置する場合は、エンドベースを使用してください。
※L型連結支柱、3方向連結支柱、4方向連結支柱にはあらかじめベースが取り付けてありますのでベースは必要ありません。
・ドアパネルを設置する場合
・直線で使用する場合、ドアパネルの両端に直接連結支柱と両面用ベース、エンドベース、丸ベースのいずれかを1本取り 付けてください。
・L型、3方向、4方向で使用する場合、L型連結支柱、3方向連結支柱、4方向連結支柱のいずれかを1本取り付けてください。
・高さ調整機能について
・ベースには高さ調整機能(アジャスター)はありません。床面に起伏がある場所で使用するとがたつきが発生する可能性があ ります。
・本体と支柱はマグネット連結のため連結位置を上下に多少調整することができますので、パネルの連結時に多少のずれが生 じた場合はパネル上部を水平にそろえるときれいにならべることができます。
174
・直線で設置する場合
・直線連結の長さは、3600mmまでにしてください。
H1800
・両端及びパネル2枚ごとに直線連結支柱と両面用ベース、 エンドベース、丸ベースのいずれかを1本取り付けてください。
チェアデスク・収納パーティションテーブルレセプションロビーエクステリアアクセサリー木工
A
※パネルを1枚だけで使用する場合、両端に直線連結支柱と 両面用ベース、エンドベース、丸ベースのいずれかが必要です。
直線連結
パーツ 数量 パネル本体4枚 直線連結支柱5本 直線ストッパー3個 エンドストッパー2個 両面用ベース1個 エンドベース2個 75角ベース2個
・L字型に設置する場合 ・コの字型に設置する場合
・長い辺Aは3600mmまでにしてください。
・短い辺Bが1200mm未満の場合、コーナー外側に直線連結支 柱と両面用ベース、エンドベース、丸ベースのいずれかを1本取 り付けてください。
・連結パネルが2枚以上になる場合、両端及びパネル2枚ごと に直線連結支柱と両面用ベース、エンドベース丸ベースのいずれ かを1本取り付けてください。
L字型連結
パーツ 数量 パネル本体6枚 直線連結支柱6本 L型連結支柱1本 直線ストッパー4個 L型ストッパー1個 エンドストッパー2個 両面用ベース1個 エンドベース2個
75角ベース3個
コの字型連結
パーツ 数量 パネル本体8枚 直線連結支柱7本 L型連結支柱2本 直線ストッパー5個 L型ストッパー2個 エンドストッパー2個 両面用ベース1個 エンドベース2個 75角ベース4個
175 SOCIA
A B A B A B A B A B
幼保レンタル・リース
B
B
H2100 A
マグネットパーティション

磁石の力で連結ができるマグネットパーティション。


連結はパネル側面に内蔵されたマグネッ トによって工具なしで簡単に連結する ことが可能です。

磁力の力で連結をするので、パネル同 士の連結に限らず、スチール書庫やス チールロッカーなどにも着磁させること ができます。

床面からパネルまでの高さは 31mmです。

WT:ウォールナット IV:アイボリー ■カラーサンプル

NA:ナチュラル


MAK:ミディアムオーク

CR:クリア

パネル部 ポリカーボネイト(CR) 自然光を取り込みスペースの明るさを 保ちつつ、適度なプライバシー空間 をつくるのに最適な、半透明のクリ アパネル。
デスク FDC-2412W(NA) P.204
SMP-1809AR+SMP-FK
YSC01(GR)
SMP-1809AR+SMP-F
SMP-1809MP(MAK)
チェア CK02(OR) P.080
チェア ALES-CTB(BR) P.118
チェア SFS-430(BR) P.131
チェア
PLC-120L P.097
SMP-1809AR+SMP-F
176

SMPパネル
H1800mm
チェアデスク・収納パーティションテーブルレセプションロビーエクステリアアクセサリー木工




マグネットパーティション 価格(税抜)サイズ(mm)梱包才数梱包重量
SMP-1809MP 44,700円 W900×D20×H1825 ▲ 2.4才13.7kg
SMP-1806MP 34,000円 W600×D20×H18251.6才 10.6kg
仕様/枠:スチ-ル 粉体塗装 (シルバ-) パネル:MDF (t4mm) 塩ビシ-ト貼り 入数:1
H1500mm




マグネットパーティション 価格(税抜)サイズ(mm)梱包才数梱包重量
SMP-1509MP 38,900円 W900×D20×H15252.0才 11.7kg
SMP-1506MP 29,400円 W600×D20×H15251.4才 8kg
仕様/枠:スチ-ル 粉体塗装 (シルバ-) パネル:MDF (t4mm) 塩ビシ-ト貼り 入数:1
ポリカーボネイトパネル



マグネットパーティション 価格(税抜)サイズ(mm)梱包才数梱包重量
SMP-1809PC(CR) 44,700円 W900×D20×H1825 ▲ 2.4才9kg
SMP-1806PC(CR) 34,000円 W600×D20×H18251.6才8kg
SMP-1509PC(CR) 38,900円 W900×D20×H15252.0才7kg
SMP-1506PC(CR) 29,400円 W600×D20×H15251.4才5kg
仕様/枠:スチ-ル 粉体塗装 (シルバ-) パネル:ポリカ-ボネイト (クリア-フロスト) 入数:1
アクリルパネル

幼保レンタル・リース

マグネットパーティション 価格(税抜)サイズ(mm)梱包才数梱包重量
SMP-1809AR 45,900円 W900×D20×H1825 ▲ 2.6才13.4kg
SMP-1509AR 39,800円 W900×D20×H15252.2才11.4kg
仕様/枠:スチ-ル 粉体塗装 (シルバ-) パネル:AR/アクリル樹脂
(t3.0mm) 入数:1
SMP-1809PC(CR)SMP-1806PC(CR)SMP-1509PC(CR)
SMP-1509MP(WT)
SMP-1809MP(WT)
SMP-1509MP(NA)
SMP-1806MP(NA)
SMP-1509MP(MAK)
SMP-1806MP(MAK)
SMP-1509MP(IV)
SMP-1809MP(IV)
SMP-1809AR + SMP-F×2
SMP-1509AR + SMP-F×2
177 SOCIA
SMPキャスター脚セットパネル

SMP-1809MP(WT) + SMP-FK×2 52,700円(税抜)

SMP-1809AR + SMP-FK×2 53,900円(税抜)

SMP-1509PC(CR) + SMP-FK×2 46,900円(税抜)
SMPアジャスター脚セットパネル

SMP-1809MP(NA) + SMP-F×2 52,300円(税抜)

SMP-1809AR + SMP-F×2 53,500円(税抜)
連結金具 安定脚






SMP-1509PC(CR) + SMP-F×2 46,500円(税抜)

SMP安定脚 (キャスター脚) 価格(税抜)梱包才数梱包重量
SMP連結金具セット (上部用・下部用)
価格(税抜)サイズ(mm) SMP-SJ
仕様/本体:スチ-ル 粉体塗装 (シルバ-) 入数:1 ●上記価格は、1セット (上部・下部用) 2個入りになります。 ※連結金具をお使いの際は必ずパネルの上下 (マグネット取付部2ヵ所) に 取り付けてください。
SMP三ツ折衝立

SMP-FK 4,000円 0.1才1.1kg
仕様/本体:スチ-ル 粉体塗装 (シルバ-) キャスタ-:樹脂成型品 入数:1 ●キャスタ-仕様の場合、パネル高が42mm高くなります。 ※キャスタ-脚仕様でのご使 用の場合、連結金具は使用できません。SMP-FKに関しましては単体パルでのご使用に限 りお使いください。
SMP安定脚 (アジャスター脚) 価格(税抜)梱包才数梱包重量
SMP-F 3,800円 0.1才1kg 仕様/本体:スチ-ル 粉体塗装 (シルバ-) アジャスタ-:樹脂成型品 入数:1 ●アジャスタ-仕様の場合、パネル高は変わりません。
様々なシーンに合わせやすいブルーと仕切りの向こうに人の気配を感じさせるような クリアの2種類をシチュエーションに合わせてお選びいただけます。
パネルのジョイント部には、樹脂プレートが入っており、 隙間をつくりません。

SMP三つ折パーティション 価格(税抜)サイズ(mm)梱包才数梱包重量
SMP-3CL(BL) 108,000円 W1800×D400×H1725 ▲ 3.6才24.4kg
仕様/パネル枠:スチ-ル 粉体塗装 (シルバ-) 幕部:布 (ブル-) 入数:1 ●折畳時:W595×D400× H1725 ●マグネット連結機能付 ●両方向に360°回転が可能 ●キャスタ-:(大) ストッパ-付、(大) ストッ パ-無、(小) 各2個


SMP三つ折パーティション 価格(税抜)サイズ(mm)梱包才数梱包重量
SMP-3PC(CR) 100,000円 W1800×D400×H1725 ▲ 3.6才20kg 仕様/パネル枠:スチ-ル 粉体塗装 (シルバ-) 幕部:ポリカ-ボネイト (クリア-フロスト) 入数:1 ●折畳時:W595×D400×H1725 ●マグネット連結機能付 ●両方向に360°回転が可能 ●キャスタ-: (大) ストッパ-付、(大) ストッパ-無、(小) 各2個
3,900円 直線連結
3,900円 L型連結
6,800円 4方向連結 SMP-3J 5,800円 3方向連結
SMP-LJ
SMP-4J
SMP-SJ 直線連結 SMP-LJ L型連結
SMP-3J 3方向連結 SMP-4J 4方向連結
SMP-FK SMP安定脚(キャスター脚) SMP-F SMP安定脚(アジャスター脚)
SMP-3CL(BL)SMP-3PC(CR) 折り畳み時
178
折り畳み時
SMPシリーズ SMPシリーズ
SMPシリーズ SMPシリーズ
チェアデスク・収納パーティションテーブルレセプションロビーエクステリアアクセサリー木工
◎注意事項
連結金具をお使いの際は、必ずパネルの上下(マグネット取付 部2ヶ所)に取り付けてください。
・キャスター脚仕様でのご使用の場合、連結金具は使用できま せん。SMP-FKに関しましては、単体パネルでのご使用に限 りお使い下さい。
マグネット同士の反発を防ぐため、連結の際に、パネル側面のマグ ネットは重なり合わないようになっています。
パネルモジュール
H1800…立った状態でも視線が遮られる高さ。
H1500…座ると周囲から視線が遮られ、立った状態で見渡せる高さ。
H1500 ㎜
H1800 ㎜
パネル1枚[安定脚(アジャスター脚)]
パーツ 数量 ①パネル本体1枚 ②安定脚(アジャスター脚)2本
パネル1枚[安定脚(キャスター脚)]
パーツ 数量 ①パネル本体1枚 ②安定脚(キャスター脚)2本
2方向(直線)連結
パーツ 数量 ①パネル本体3枚 ②安定脚(アジャスター脚)3本 ③連結金具セット(直線)2set
コの字型連結
パーツ 数量 ①パネル本体7枚 ②安定脚(アジャスター脚)3本 ③連結金具セット(直線)4set ④連結金具セット(L型)2set
高さ違い連結1
パーツ 数量 ①パネル本体1枚 ②パネル本体1枚 ③安定脚(アジャスター脚)2本 ④連結金具セット(直線)1set
2方向(L字)連結
パーツ 数量 ①パネル本体5枚 ②安定脚(アジャスター脚)3本 ③連結金具セット(直線)3set ④連結金具セット(L型)1set
4方向(十字)連結
パーツ 数量 ①パネル本体8枚 ②安定脚(アジャスター脚)4本 ③連結金具セット(直線)4set ④連結金具セット(4方向)1set
高さ違い連結2
幼保レンタル・リース
パーツ 数量 ①パネル本体4枚 ②パネル本体1枚 ③安定脚(アジャスター脚)2本 ④連結金具セット(直線)2set ⑤連結金具セット(3方向)1set ⑤ ① ③ ④ ② ① ③ ④ ②
マグネット位置 ↓ SMPシリーズ SMPシリーズSMPシリーズ
179 SOCIA

折り畳みパーティション

360度折畳

連結部 連結部に隙間が出来ない仕様になっ ています。
パネル交換 本体上部のボルトを外すだけで簡単にパネ ルが交換できます。

折畳時 特殊機構により360度開閉可能で パネルの連結部に隙間をつくりません。
2連仕様承ります。















KPVパネルは2連仕様での製作が可能です。 サイズにつきましては、お気軽にお問い合わせください。 ※2連仕様につきましては別途お見積もり致します。

パネル
KPV-18-2V(DBR) WH:ホワイト NA:ナチュラル MAK:ミディアムオーク DBR:ダークブラウン BR:ブラウン 抗ウイルスメラミン化粧板 OR:オレンジ GR:グレイ GN:グリーン BL:ブルー BJ:ベージュ 防炎布 IV:アイボリー NA:ナチュラル WT:ウォールナット BR:ブラウン ポリ化粧板 ■カラーサンプル
180
ASO-WC1(BL)
3連
H2100
チェアデスク・収納パーティションテーブルレセプションロビーエクステリアアクセサリー木工

KPV-21-3P(IV)
KPV-21-3F
KPV-18-3V
H1800

H1500

パーティション3連 価格(税抜)サイズ(mm)梱包才数梱包重量
KPV-15-3V 259,000円 W1803×D450×H15005.9才21.9kg
KPV-15-3P 210,000円 W1803×D450×H15005.9才21.9kg
KPV-15-3P(IV) 184,000円 W1803×D450×H15005.9才21.9kg
KPV-15-3F 198,000円 W1803×D450×H15005.9才21.9kg 仕様/パネル:F/布、P/ポリエステル化粧板、V/抗ウイルスメラミン化粧板 パネル枠:アルミ 脚:スチ-ル メラミン焼付塗装 (シルバ-) 入数:1 ●折畳時:W629×D450×H1500 ●キャスタ-:φ50mm ストッパ-付
KPV-18-3P 210,000円 W1803×D450×H18006.8才26kg
KPV-18-3P(IV) 184,000円 W1803×D450×H18006.8才26kg
KPV-18-3F 204,000円 W1803×D450×H18006.8才26kg 仕様/パネル:F/布、P/ポリエステル化粧板、V/抗ウイルスメラミン化粧板 パネル枠:アルミ 脚:スチ-ル メラミン焼付塗装 (シルバ-) 入数:1 ●折畳時:21/W629×D450×H2100、 18/W629×D450×H1800 ●キャスタ-:φ50mm ストッパ-付
4連
H2100

H1800

H1500

パーティション4連 価格(税抜)サイズ(mm)梱包才数梱包重量
KPV-15-4V 352,000円 W2400×D450×H1500 ▲ 7.9才28.2kg
KPV-15-4P 289,000円 W2400×D450×H1500 ▲ 7.9才28.2kg
KPV-15-4P(IV) 249,000円 W2400×D450×H1500 ▲ 7.9才28.2kg
幼保レンタル・リース
KPV-15-4F 267,000円 W2400×D450×H1500 ▲ 7.9才28.2kg
仕様/パネル:F/布、P/ポリエステル化粧板、V/抗ウイルスメラミン化粧板 パネル枠:アルミ 脚:スチ-ル メラミン焼付塗装 (シルバ-) 入数:1 ●折畳時:W681×D450×H1500 ●キャスタ-:φ50mm ストッパ-付
KPV-18-4F
仕様/パネル:F/布、P/ポリエステル化粧板、V/抗ウイルスメラミン化粧板 パネル枠:アルミ 脚:スチ-ル メラミン焼付塗装 (シルバ-) 入数:1 ●折畳時:21/W618×D450×H2100、 18/W618×D450×H1800 ●キャスタ-:φ50mm ストッパ-付
中野 2023.9.4 587629587 450 150 0/ 180 0/ 2100 1803 1500 635 450 25 折り畳み時 545587681587 450 150 0/ 180 0/ 2100 2400 1500 690 475 25 折り畳み時 パーティション3連 価格(税抜)サイズ(mm)梱包才数梱包重量 KPV-21-3V 273,000円 W1803×D450×H2100 ▲ 7.8才29kg KPV-21-3P 234,000円 W1803×D450×H2100 ▲ 7.8才29kg
192,000円 W1803×D450×H2100 ▲ 7.8才29kg
221,000円 W1803×D450×H2100 ▲ 7.8才29kg
263,000
W1803×D450×H18006.8才26kg
円
パーティション4連 価格(税抜)サイズ(mm)梱包才数梱包重量 KPV-21-4V 369,000円 W2400×D450×H2100 ▲ 10.5才38.3kg KPV-21-4P 325,000円 W2400×D450×H2100 ▲ 10.5才38.3kg KPV-21-4P(IV) 256,000円 W2400×D450×H2100 ▲ 10.5才38.3kg KPV-21-4F 294,000円 W2400×D450×H2100 ▲ 10.5才38.3kg KPV-18-4V 352,000円 W2400×D450×H1800 ▲ 9.2才 ▲ 33.2kg KPV-18-4P 289,000円 W2400×D450×H1800 ▲ 9.2才 ▲ 33.2kg KPV-18-4P(IV) 248,000円 W2400×D450×H1800 ▲ 9.2才 ▲ 33.2kg
280,000円 W2400×D450×H1800 ▲ 9.2才 ▲ 33.2kg
KPV-21-3P(IV)
KPV-21-4P(NA)KPV-18-4V(BR)KPV-15-4F(GN)
KPV-18-3V(MAK)KPV-15-3F(BL)
181 SOCIA
パネルモジュール
H1500・・・座ると周囲から視線が遮られ、立った状態で見渡せる高さ。
カフェスペース
1500
H1800・・・立った状態でも視野が遮られる高さ。
ミーティングスペース
1800
H2100・・・壁として空間を仕切ることが出来る高さ。
展示会/ブース設営
外面と内面のパネルのカラーを変えたり、指定の 面だけを異なるカラーに変えたりして、印象の違 う空間を作ることも出来ます。
※ 多色カラー仕様につきましては別途お見積い たします。 ■カラーの組み合わせ
■パネルの交換
パネルの汚れや破損の多い展示会などでの使用 でも、傷んだ面のパネルを交換するだけで一新! 一台で長くお使いいただけます。
外面/ナチュラル 内面/ブルー パネル

使用しない時には、折りたたんでスッキリ収納!

KPV-2100/1800/1500-3 KPV-2100/1800/1500-4
2100 受付
KPV-1800-4
587629587 450 150 0/ 180 0/ 2100 1803 1500 635 450 25 折り畳み時 545587681587 450 150 0/ 180 0/ 2100 2400 1500 690 475 25 折り畳み時 182
KPV-1800-3
チェアデスク・収納パーティションテーブルレセプションロビーエクステリアアクセサリー木工

VNR
H2000mm

VNR-88K(BL)
■カラーサンプル


IV アイボリー BL ブルー
抗ウイルス壁紙
抗ウイルス壁紙
1.壁紙表面に付着したウイルスへの効果 抗ウイルス性成分が、ウイルス表層のタンパク質を変性・破壊し、さら に有機成分を分解。壁紙表面に付着したウイルスに効果があります。 2.抗菌性にも優れ、よりよい衛生環境に ウイルスだけでなく、細菌の繁殖を抑制する働きもあり、よりよい衛 生環境づくりをお手伝いします。
パネル表面に抗ウイルス壁紙を採用した抗ウイルス三つ折衝立です。 移動・設置が簡単で収納にも場所を取りません。

VNR-88K(IV)
抗ウイルス三ツ折衝立 価格(税抜)サイズ(mm)梱包才数梱包重量 VNR-88K 128,000円 W1800×D400×H2000 ▲ 6.1才28.5kg 仕様/パネル枠:アルミ押出成型品 アルマイト仕上げ パネル:フラッシュ合板 抗ウイルスビニ-ル壁紙 脚:アル ミダイガスト 入数:1 折畳時:W620×D400×H2000 ●別注にてボ-ルキャスタ- (ストッパ-付) 変更可能

H1720mm

VNR-66K(BL)

VNR-66K(IV)
折り畳み例 床面からパネルまでの高さは 144mmです。


幼保レンタル・リース
抗ウイルス三ツ折衝立 価格(税抜)サイズ(mm)梱包才数梱包重量 VNR-66K 116,000円 W1800×D400×H17205.3才25kg 仕様/パネル枠:アルミ押出成型品 アルマイト仕上げ パネル:フラッシュ合板 抗ウイルスビニ-ル壁紙 脚:アル ミダイガスト 入数:1 折畳時:W620×D400×H1720 ●別注にてボ-ルキャスタ- (ストッパ-付) 変更可能
183 SOCIA
楢(布/防炎布張りタイプ)

軽量なアルミフレームで設置、移動が簡単に行えます。
折りたたみ式で効率よく収納可能。
布張りタイプ




三ッ折衝立 価格(税抜)サイズ(mm)梱包才数梱包重量 楢-88C 154,000円 W1800×D400×H2000 ▲ 6.0才28.5kg
楢-66C 138,000円 W1800×D400×H17205.3才25kg
仕様/パネル部:フラッシュ合板 表面布張り パネル枠:アルミ押出成型品 アルマイト仕上げ 脚:アルミダイカ スト 入数:1 88C折畳時:W620×D400×H2000・66C折畳時:W620×D400×H1720 ●別注にてストッパ-付に変更可能。
■カラーサンプル





■カラーサンプル(防炎加工)





折り畳み例


144mm
床面からパネルまでの高さは 144mmです。
防炎布張りタイプ




三ッ折衝立 価格(税抜)サイズ(mm)梱包才数梱包重量
楢-88CB 162,000円 W1800×D400×H2000 ▲ 6.0才28.5kg
楢-66CB 144,000円 W1800×D400×H17205.3才25kg
仕様/パネル部:フラッシュ合板 表面布張り パネル枠:アルミ押出成型品 アルマイト仕上げ 脚:アルミダイカ スト 入数:1 88CB折畳時:W620×D400×H2000・66CB折畳時:W620×D400×H1720 ●別注にてストッパ-付に変更可能。

グリーン ブルー オレンジ グレー ベージュ
グリーン ブルー
オレンジ グレー ベージュ
楢-66C(オレンジ)楢-66C(ブルー)楢-88CB(グリーン)楢-88CB(グレー)
184
楢-66C(グリーン)楢-66C(ベージュ)楢-88CB(オレンジ)楢-88CB(ベージュ)
チェアデスク・収納パーティションテーブルレセプションロビーエクステリアアクセサリー木工

楢-88(ホワイト)
楢(ポリ化粧板タイプ)

楢-66(ナチュラル)



ウォールナット




楢-88(ホワイト)
144mm

折り畳み例 床面からパネルまでの高さは 144mmです。
楢-66(ウォールナット)楢-66(アイボリー)
三ッ折衝立 価格(税抜)サイズ(mm) 梱包才数梱包重量

楢-66(ナチュラル/ウォールナット) 170,000円 W1800×D400×H17205.3才 25kg
楢-66(ホワイト) 151,000円 W1800×D400×H17205.3才 25kg
楢-66(アイボリー) 135,000円 W1800×D400×H17205.3才 25kg
仕様/パネル部:ポリエステル化粧板 パネル枠:アルミ押出成型品 アルマイト仕上げ 脚:アルミダイカスト 入数:1 ●折畳時:W620×D400×H1720 ●別注にてストッパ-付に変更可能。


楢-88(ナチュラル)楢-88(ウォールナット)
幼保レンタル・リース
三ッ折衝立 価格(税抜)サイズ(mm) 梱包才数梱包重量 楢-88(ナチュラル) 192,000円 W1800×D400×H2000 ▲ 6.0才 28.5kg 楢-88(ウォールナット) 190,000円 W1800×D400×H2000 ▲ 6.0才 28.5kg
楢-88(ホワイト) 168,000円 W1800×D400×H2000 ▲ 6.0才 28.5kg 楢-88(アイボリー) 146,000円 W1800×D400×H2000 ▲ 6.0才 28.5kg
仕様/パネル部:ポリエステル化粧板 パネル枠:アルミ押出成型品 アルマイト仕上げ 脚:アルミダイカスト 入数:1 ●折畳時:W620× D400×H2000 ●別注にてストッパ-付に変更可能。
ナチュラル ホワイト アイボリー ■ポリ板カラーサンプル 185 SOCIA
抗ウイルススクリーン
抗ウイルス・抗菌機能付きクロススクリーンです。 増結可能で多彩なアレンジが可能です。

ASO-SP
3連パネル

単体パネル

抗菌・抗ウイルス
●約20種類の微生物(細菌・真菌・ウィルス)に対する効果を確認し ています。
●例えば、生乾きの嫌なニオイの原因になる細菌にも。
●効果はすべて繊維状の微生物に対するものです。


間仕切りとしてだけでなく、ラウンジソファとの組み合わせで集中 ワークエリアやプライベート感のあるエリアが設置可能です。



抗ウィルススクリーン 3連 価格(税抜) サイズ(mm)梱包才数梱包重量
ASO-SP3B 135,000円 W700×D20×H1500×3枚1.9才12kg
ASO-SP3W 135,000円 W700×D20×H1500×3枚1.9才12kg 仕様/パネル:布 パネル枠:スチ-ル 粉体塗装 入数:1 ●連結可能 ●アジャスタ-付




抗ウイルススクリーン 増設 価格(税抜) サイズ(mm)梱包才数梱包重量
ASO-SP1B 46,000円 W700×D20×H15000.6才4kg
ASO-SP1W 46,000円 W700×D20×H15000.6才4kg
仕様/パネル:布 パネル枠:スチ-ル 粉体塗装 入数:1 ●連結可能 ●アジャスタ-付
抗菌・抗ウイルス機能繊維加工技術「CLEANSE®/クレンゼ®」は、固定化抗菌成分「Etak®/イータック」を 活用し、繊維表面に強力に固定化するクラボウ独自の加工技術です。
 ASO-SP1B/ SP1W
ASO-SP1B/ SP1W
中野 2021.10.22
X 0.015 675 (内寸) 1400 700 (外寸) 700 (内寸) 750 (外寸) 675 (内寸) 700 (外寸) 700 23 655 350 750 1500 400 85 700 655 350 750 1500 400 85
ASO-SP3B/ SP3W
抗ウイルススクリーン
SP3W ASO-SP1B/ SP1W 23 675 (内寸) 1400 700 (外寸) 700 (内寸) 750 (外寸) 675 (内寸) 700 (外寸) 700 23 655 350 750 1500 400 85 700 655 350 750 1500 400 85
ASO-SP3B/
ASO-SP3B/ SP3W
23
ASO-SP1B/ SP1W
ASO-SP3B(GR)
ASO-SP3B(NV)
ASO-SP3W(GR)ASO-SP3W(NV)
ASO-SP1W(NV)ASO-SP1B(NV)ASO-SP1B(GR) ASO-SP1W(GR)
ASO-SP1W/SP1B
ASO-SP3W/SP3B
NV:ネイビー GR:グレー ■カラーサンプル
ASO-ST400B(MAK)
ASO-OC1(GR)
186
ASO-LS600S(PK)
チェアデスク・収納パーティションテーブルレセプションロビーエクステリアアクセサリー木工

木目単体パネル SKN
アジャスタータイプ

■カラーサンプル

NA:ナチュラル

LWT:ライトウォールナット

HWH:ヒッコリーホワイト

キャスタ- (1set 4個入) 価格(税抜) サイズ(mm) 梱包才数梱包重量
SPJ-0001 1,600円 W40×D49×H53 0.3才2kg 仕様/φ40mm双輪ナイロン樹脂キャスタ- 入数:10 ●ストッパ-付2個、ストッパ-無2個
簡易的な仕切りに最適な自立型の木製パーティション。 オプションのキャスターに取り換えることで移動も簡単。


※キャスターはオプションになります。

自立パネル (両面木目) 価格(税抜)サイズ(mm)梱包才数梱包重量
SKN-1812SK(NA) 54,000円 W1180×D400×H1800 ▲ 3.5才16.4kg
仕様/パネル:MDF ペ-パ-ハニカムコア フラッシュ加工 プリント化粧板貼り パネル厚:30mm 脚:スチ-ル メラミン焼付塗装 (シルバ-) 入数:1 ●アジャスタ-付
キャスタータイプ

自立パネル (両面木目)
キャスター仕様
価格(税抜)サイズ(mm)梱包才数梱包重量 SKN-1812SK+SPJ-0001 55,600円 W1180×D400×H1845 ▲ 3.5才16.4kg 仕様/パネル:MDF ペ-パ-ハニカムコア フラッシュ加工 プリント化粧板貼り パネル厚:30mm 脚:スチ-ル メラミン焼付塗装 (シルバ-) 入数:1 ●キャスタ-:φ40mm 双輪ナイロン樹脂キャスタ- (ストッパ-付2個、ス トッパ-無2個)
自立パネル (両面木目) 価格(税抜)サイズ(mm)梱包才数梱包重量 SKN-1809SK(HWH/LWT) 38,000円 W880×D400×H1800 ▲ 2.6才13kg 仕様/パネル:MDF ペ-パ-ハニカムコア フラッシュ加工 プリント化粧板貼り パネル厚:30mm 脚:スチ-ル メ ラミン焼付塗装 (シルバ-) 入数:1 ●アジャスタ-付 ● (LWT) と (HWH) は抗菌



自立パネル (両面木目)キャスター仕様 価格(税抜)サイズ(mm)梱包才数梱包重量 SKN-1809SK+SPJ-0001
39,600円 W880×D400×H1845 ▲ 2.6才13kg 仕様/パネル:MDF ペ-パ-ハニカムコア フラッシュ加工 プリント化粧板貼り パネル厚:30mm 脚:スチ-ル メラミン焼付塗装 (シルバ-) 入数:1 ●キャスタ-:φ40mm 双輪ナイロン樹脂キャスタ- (ストッパ-付2個、 ストッパ-無2個) ● (LWT) と (HWH) は抗菌
SPJ-0001
SKN-1812SK(NA)
SKN-1812SK(NA)+SPJ-0001
SKN-1809SK(NA)
SKN-1809SK(NA)+SPJ-0001
SKN-1809SK(LWT)
SKN-1809SK(LWT)+SPJ-0001
SKN-1809SK(HWH)
SKN-1809SK(HWH)+SPJ-0001
チェア SFIDA-C1(BL) P.106
SKN-11809SK(HWH)
187 SOCIA
SKN-1809SK(LWT)+SPJ-0001
幼保レンタル・リース

両面有孔ボード展示パネル タテヨコどちらでも使用できます。
展示物に合わせてレイアウト変更が可能。
TEM




■ピン・マグカラーサンプル

WH:ホワイト

取付説明
支柱の組付金具にパネル側のフックを落とし込むことで連結が可能。
両面ピン・マグ展示 パネル 価格(税抜)サイズ(mm)梱包才数梱包重量 TEM-1809 121,500円 W940×D30×H1815 ▲ 2.6才 11kg
TEM-1209 93,700円 W940×D30×H12151.7才 8.2kg
仕様/パネル:LVL合板 発泡スチロ-ル 鉄箔 (t0.08mm) PVC張り 枠フレ-ム:アルミ 入数:1
●タテでもヨコでもお使いいただけます。 ●ピン・マグネット使用可能(マグネットは種類や挟む物の厚みにより、貼り付け 強度が落ちる場合があります) ●マグネット2個付




マグネット 価格(税抜)梱包重量
TEM-MG 900円 0.1kg 仕様/ポリ塩化ビニ-ル マグネット 入数:1
支柱 価格(税抜)サイズ(mm)梱包才数梱包重量 TEP-JK 10,000円 W40×D40×H18451.3才 22.8kg
仕様/本体:スチ-ル 粉体塗装 入数:6
丸ベース 価格(税抜)サイズ(mm)梱包才数梱包重量
TEP-RB 12,300円 φ380×H2050.2才 10kg
仕様/本体:スチ-ル 粉体塗装 入数:2
安定脚 価格(税抜)サイズ(mm)梱包才数梱包重量
TEP-SB 5,700円 W80×D500×H2051.5才 4.2kg
パネル フック 連結金具 フック ポ ル 原寸大
フック ポ
パネル
仕様/本体:スチ-ル 粉体塗装 入数:2
TEM-1809(WH)TEM-1209(WH)
連結金具用穴
TEP-JK TEP-RBTEP-SB
TEPストッパー
188
両面有孔ボード展示パネル
チェアデスク・収納パーティションテーブルレセプションロビーエクステリアアクセサリー木工

TEY

ASO-L03W(LGN)
取付説明

TEY-1809(IV)TEY-1209(IV)

・穴径:φ5mm ・穴ピッチ:25mm
支柱の組付金具にパネル側のフックを落とし込むことで連結が可能。
両面有孔ボード展示 パネル 価格(税抜)サイズ(mm)梱包才数梱包重量
TEY-1809 84,900円 W940×D30×H1815 ▲ 2.6才 15kg
TEY-1209 74,200円 W940×D30×H12151.7才 10.5kg
仕様/パネル:LVL合板 有孔加工ポリエステル化粧板 枠フレ-ム:アルミ 入数:1 ●タテでもヨコでもお使いいただけ ます。 ●φ5mmで 25mmピッチ ●フック3本付
オプションパーツ

幼保レンタル・リース
TEY-LHK3
有孔ボード展示パネル用L型フック (3個入り) 価格(税抜)
TEY-LHK3 1,300円
仕様/スチ-ル クロ-ムメッキ 入数:1 ●穴径:φ5mm
パネル フック 連結金具 フック ポ ル 原寸大
ポ
パネル
G-OVT16
189 SOCIA

TPA-W
和柄タイプ 和紙の様に独特な風合いの質感を用いた 和柄壁紙を採用した単体パネル

単体アルミパーティ
ション
価格(税抜)サイズ(mm)梱包才数梱包重量
TPA-W1809B 49,000円 W900×D25×H1800 ▲ 2.5才9.6kg 仕様/パネル部:ペ-パ-ハニカムコア ビニ-ル壁紙 フレ-ム:アルミ押出成型品 アルマイト仕上げ パネル厚:18mm 入数:1
共通仕様
パネル部:ペーパーハニカムコア ビニール壁紙 フレーム:アルミ押出成型品 アルマイト仕上げ パネル厚:18mm
■カラーサンプル

YE:イエロー
単体アルミパーティ ション

価格(税抜)サイズ(mm)梱包才数梱包重量
TPA-W1509B 44,000円 W900×D25×H15002.1才7.5kg 仕様/パネル部:ペ-パ-ハニカムコア ビニ-ル壁紙 フレ-ム:アルミ押出成型品 アルマイト仕上げ パネル厚:18mm 入数:1
チェア ALES-CH-B P.112
SOCIA ASO-CF7575B(NA) P.047
TPA-W1509B(YE)+TPA-RF×2
TPA-W1809B(YE)TPA-W1509B(YE)
190
チェアデスク・収納パーティションテーブルレセプションロビーエクステリアアクセサリー木工


TPA-R TPA-A
細目柄タイプ
気になる臭いを吸着・分解する壁紙を使用。
細め柄で少しラメが入っているので、カジュ アルなシーンに最適です。

TPA-R1809B
単体アルミパーティション 49,000円(税抜)
サイズ:W900×D25×H1800mm 入 数:1 梱包才数:▲ 2.5才 梱包重量:9.6kg
共通仕様
パネル部:ペーパーハニカムコア ビニール壁紙 フレーム:アルミ押出成型品 アルマイト仕上げ パネル厚:18mm

TPA-R1509B
単体アルミパーティション 44,000円(税抜)
サイズ:W900×D25×H1500mm 入 数:1 梱包才数:2.1才 梱包重量:7.5kg
■カラーサンプル


太目柄タイプ
特徴的な太目柄で防カビ機能も付いた壁紙 を使用。

TPA-A1809B
単体アルミパーティション 49,000円(税抜)
サイズ:W900×D25×H1800mm 入 数:1 梱包才数:▲ 2.5才 梱包重量:9.6kg
共通仕様
パネル部:ペーパーハニカムコア ビニール壁紙 フレーム:アルミ押出成型品 アルマイト仕上げ パネル厚:18mm

TPA-A1509B
単体アルミパーティション 44,000円(税抜)
サイズ:W900×D25×H1500mm 入 数:1 梱包才数:2.1才 梱包重量:7.5kg
幼保レンタル・リース
■カラーサンプル

 TPA-R1809B(LYE)
G-OVT16
SOCIA ASO-WC-2T(NA) P.053
TPA-A1809B(GR)
TPA-R1809B(LYE)TPA-R1509B(LPK)TPA-A1809B(GR)TPA-A1509B(BJ)
TPA-R1809B(LYE)
G-OVT16
SOCIA ASO-WC-2T(NA) P.053
TPA-A1809B(GR)
TPA-R1809B(LYE)TPA-R1509B(LPK)TPA-A1809B(GR)TPA-A1509B(BJ)
LYE:ライトイエロー LPK:ライトピンク
GR:グレー
BJ:ベージュ
191 SOCIA


TPA-M
木目柄タイプ マットな黒フレームと木目柄が マッチした単体パネル


抗ウイルス壁紙
1.壁紙表面に付着したウイルスへの効果 抗ウイルス性成分が、ウイルス表層のタンパク質を変性・ 破壊し、さらに有機成分を分解。壁紙表面に付着したウ イルスに効果があります。
2.抗菌性にも優れ、よりよい衛生環境に ウイルスだけでなく、細菌の繁殖を抑制する働きもあり、 よりよい衛生環境づくりをお手伝いします。


TPA-V1809B(BL)TPA-V1509B(BL)TPA-M1809B(WT)TPA-M1509B(NA)
TPA-V1809B
単体アルミパーティション 49,000円(税抜)
サイズ:W900×D25×H1800mm
入 数:1 梱包才数:▲ 2.5才 梱包重量:9.6kg
TPA-V1509B
単体アルミパーティション 44,000円(税抜)
サイズ:W900×D25×H1500mm
入 数:1
梱包才数:2.1才 梱包重量:7.5kg
共通仕様 パネル部:ペーパーハニカムコア ビニール壁紙 フレーム:アルミ押出成型品 アルマイト仕上げ パネル厚:18mm
■カラーサンプル

TPA-M1809B
単体アルミパーティション 49,000円(税抜) サイズ:W900×D25×H1800mm 入 数:1 梱包才数:▲ 2.5才 梱包重量:9.6kg
共通仕様 パネル部:ペーパーハニカムコア ビニール壁紙 フレーム:アルミ押出成型品 アルマイト仕上げ パネル厚:18mm
TPA-M1509B
単体アルミパーティション 44,000円(税抜)
サイズ:W900×D25×H1500mm
入 数:1
梱包才数:2.1才 梱包重量:7.5kg
■カラーサンプル

 抗ウイルスタイプ
チェア LM1(BL) P.082
TPA-V1809B(BL)
TPA-M1809B(WT)
TPA-V
抗ウイルスタイプ
チェア LM1(BL) P.082
TPA-V1809B(BL)
TPA-M1809B(WT)
TPA-V
BL:ブルー
WT:ウオールナット
NA:ナチュラル
192
アルミパーティション
チェアデスク・収納パーティションテーブルレセプションロビーエクステリアアクセサリー木工

APF-1812FK(IV)
抗菌・防臭を備えた高機能な張地を使用した 軽量アルミパーティション
APF 安定脚


アルミパーティション (安定脚タイプ) 価格(税抜)サイズ(mm)梱包才数梱包重量
APF-1812F 46,000円 W1200×D400×H18102.3才5kg
APF-1809F 45,000円 W900×D400×H18102.3才4.8kg
仕様/パネル:布 (抗菌仕様) パネル枠:アルミ押出成型品 アルマイト仕上げ 脚:スチ-ル 粉体塗装 (シルバ-) 入数:1(3個口)



キャスター脚

幼保レンタル・リース

アルミパーティション (キャスター脚タイプ) 価格(税抜)サイズ(mm)梱包才数梱包重量
APF-1812FK 47,000円 W1200×D400×H18702.4才6.2kg
APF-1809FK 46,000円 W900×D400×H18702.4才6kg 仕様/パネル:布 (抗菌仕様) パネル枠:アルミ押出成型品 アルマイト仕上げ 脚:スチ-ル 粉体塗装 (シルバ-) キャスタ-:樹脂成型品 (ストッパ-付2個、ストッパ-無2個) 入数:1(3個口)
APF-1812FK(GN)テーブル VKT-1845S(WH) P.222
APF-1812F(BL)APF-1809F(IV)APF-1812FK(BL)APF-1809FK(GN)
IV:アイボリー GN:グリーン BL:ブルー ■カラーサンプル
193 SOCIA
アコーディオンスクリーン

AA・AAC

AA-188(GL)+AAC-128(GL)

シンプルな伸縮機構でスムーズで安定した設置が可能。


AA-188(BE)・AAC-121(GR)・AA158(GL)

■カラーサンプル
BE:ベージュ


アコーディオンスクリーン 価格(税抜) サイズ(mm) 梱包才数梱包重量
AA-188 161,000円 W1800×D340×H18004.0才 18.8kg
AA-158 129,000円 W1500×D340×H18004.0才 13.4kg
AA-186 147,000円 W1800×D340×H16504.0才 18.2kg
AA-156 122,000円 W1500×D340×H16504.0才 13kg
AA-151 110,000円 W1500×D340×H11002.6才 9.1kg
AAC-128 145,000円 W600×D340×H1800×2枚4.0才 13.6kg
AAC-126 134,000円 W600×D340×H1650×2枚4.0才 12.8kg
AAC-121 118,000円 W600×D340×H1100×2枚2.6才 8.2kg 仕様/張地:ビニ-ルクロス フレ-ム:アルミ アルマイト仕上げ (ブロンズ) 脚:樹脂成型品 (ブラック) 入数:1 ●折畳時:AA186、188/W300・●折畳時:AA-156、158/W260・●折畳時:AA-151/W270・●折畳時:AAC-121、126、128/W300×2枚
GL:グレー GR:グリーン OR:オレンジ




アコーディオン式の折 り畳み構造なので、 非常にコンパクトに収 納可能です。

H1100タイプは内部構造にほこり等の 混入を防ぎ、見た目にも上質な仕上がり のカバーがついています。

幕部 張地は防炎・防汚加工


連結 フレームに取り付けられているマグネットで 連結が簡単に行えます。
AA-151(BE)
194
AAC-126(BE)
チェアデスク・収納パーティションテーブルレセプションロビーエクステリアアクセサリー木工


シンプルな伸縮機構でスムーズな可動と、安定した設置が可能。
高級感を追求しダイキャストパーツを採用し、多彩な連結も可能なシリーズです。
AX
■カラーサンプル




■梨地透過イメージ



NS:梨地






アコーディオンスクリーン 価格(税抜)サイズ(mm) 梱包才数梱包重量
AX-1920 225,000円 W1950×D470×H2000 ▲ 4.4才 19.5kg
AX-198 171,000円 W1950×D470×H1800 ▲ 4.0才 17.7kg
AX-196 152,000円 W1950×D470×H16503.7才 16.9kg
幼保レンタル・リース
AX-193 142,000円 W1950×D470×H13003.0才 14.8kg

ATタイプは、脚部センターの凹みに合わせてキャスター脚を差し込めば、コーナー連
仕様/張地:ビニ-ルクロス フレ-ム:アルミ アルマイト仕上げ (シャンパンゴ-ルド) 脚:アルミダイカスト (キャスタ-付) 入数:1 ●折畳時:W350


結が可能です。直線・L型・T型・+型連結が可能です。 内部はパンタグラフ構造で、スムーズな 開閉と高い耐久性を実現。 H1300タイプは内部構造にほこり等の 混入を防ぎ、見た目にも上質な仕上がり のカバーがついています。
AX-198(NS)
AX-193(IV)・AX-196(PK)・AX-198(GR)・AX-1920(GL)
IV:アイボリー
GL:グレー PK:ピンク
AX-196(IV)
195 SOCIA
AX-193(IV)
スクリーン衝立

ブルー




アジャスター脚 ※ベージュ、ブルー、ピンク、グリーンの4色からお選びいただけます。


スクリーン衝立 (一本立) 価格(税抜) サイズ(mm)梱包才数梱包重量
AS-180 44,700円 W1800×D370×H15301.0才7kg
AS-150 40,000円 W1500×D370×H15300.9才6.5kg



AS-120 34,700円 W1200×D370×H15300.7才6kg
AS-90 28,900円 W900×D370×H15300.7才5kg


仕様/フレ-ム:スチ-ルパイプ クロ-ムメッキ 入数:1 ●防炎加工布タイプもあります ●アジャスタ-仕様
スクリーン衝立 折畳み (二ツ折) 価格(税抜) サイズ(mm)梱包才数梱包重量
AS-66-2 40,200円 W450×D370×H1800×2枚3.0才7.5kg
AS-56-2 37,000円 W450×D370×H1530×2枚2.5才6.5kg
AS-46-2 33,000円 W450×D370×H1260×2枚2.1才5kg


仕様/フレ-ム:スチ-ルパイプ クロ-ムメッキ 入数:1 ●防炎加工布タイプもあります ●アジャスタ-仕様
スクリーン衝立 折畳み (三ツ折) 価格(税抜) サイズ(mm)梱包才数梱包重量
AS-66-3 55,800円 W450×D370×H1800×3枚3.0才10kg
AS-56-3 51,600円 W450×D370×H1530×3枚2.7才9kg
AS-46-3 45,900円 W450×D370×H1260×3枚2.1才7kg


仕様/フレ-ム:スチ-ルパイプ クロ-ムメッキ 入数:1 ●防炎加工布タイプもあります ●アジャスタ-仕様
スクリーン衝立 折畳み (四ツ折) 価格(税抜) サイズ(mm)梱包才数梱包重量
AS-66-4 69,800円 W450×D370×H1800×4枚4.0才13kg
AS-56-4 68,000円 W450×D370×H1530×4枚3.5才11kg
AS-46-4 59,600円 W450×D370×H1260×4枚28.0才9kg
仕様/フレ-ム:スチ-ルパイプ クロ-ムメッキ 入数:1 ●防炎加工布タイプもあります ●アジャスタ-仕様
グリーン ピンク
ベージュ ■カラーサンプル
AS-56-4
ブルー
AS-56-3 ピンク
AS-46-2 ベージュ
AS-180 グリーン
AS-180 ブルー
AS-46-2 グリーン
AS-56-3 グリーン
AS-56-4 ベージュ
AS-180 ピンク
AS-46-2 ブルー
AS-56-3 ベージュ
196
AS-56-4 ピンク
キャスター脚 ※ベージュ、ブルー、ピンク、グリーンの4色からお選びいただけます。
チェアデスク・収納パーティションテーブルレセプションロビーエクステリアアクセサリー木工






※防災加工布に変更することも可能です
スクリーン衝立 (一本立) 価格(税抜) サイズ(mm)梱包才数梱包重量
AS-180K 45,600円 W1800×D370×H15601.0才7kg
AS-150K 41,000円 W1500×D370×H15600.9才6.5kg
AS-120K 36,200円 W1200×D370×H15600.7才6kg
AS-90K 30,900円 W900×D370×H15600.7才5kg

仕様/フレ-ム:スチ-ルパイプ クロ-ムメッキ 入数:1 ●防炎加工布タイプもあります ●キャスタ-仕様

スクリーン衝立 折畳み (二ツ折) 価格(税抜) サイズ(mm)梱包才数梱包重量
AS-66-2K 42,600円 W450×D370×H1830×2枚3.0才7.5kg
AS-56-2K 39,200円 W450×D370×H1560×2枚2.5才6.5kg
AS-46-2K 35,300円 W450×D370×H1290×2枚2.1才5kg
仕様/フレ-ム:スチ-ルパイプ クロ-ムメッキ 入数:1 ●防炎加工布タイプもあります ●キャスタ-仕様


スクリーン衝立 折畳み (三ツ折) 価格(税抜) サイズ(mm)梱包才数梱包重量
AS-66-3K 58,300円 W450×D370×H1830×3枚3.0才10kg
AS-56-3K 54,800円 W450×D370×H1560×3枚2.7才9kg
AS-46-3K 48,600円 W450×D370×H1290×3枚2.1才7kg
仕様/フレ-ム:スチ-ルパイプ クロ-ムメッキ 入数:1 ●防炎加工布タイプもあります ●キャスタ-仕様

幼保レンタル・リース

スクリーン衝立 折畳み (四ツ折) 価格(税抜) サイズ(mm)梱包才数梱包重量
AS-66-4K 73,900円 W450×D370×H1830×4枚4.0才13kg
AS-56-4K 71,700円 W450×D370×H1560×4枚3.5才11kg
AS-46-4K 64,400円 W450×D370×H1290×4枚28.0才9kg
仕様/フレ-ム:スチ-ルパイプ クロ-ムメッキ 入数:1 ●防炎加工布タイプもあります ●キャスタ-仕様
AS-46-4K グリーン
AS-46-3K ベージュ
AS-46-2K ブルー
AS-150K ピンク
AS-150K グリーン
AS-46-2K ピンク
AS-46-3K ピンク
AS-46-4K ブルー
AS-150K ベージュ
AS-46-2K グリーン
AS-46-3K ブルー
AS-46-4K ベージュ
197 SOCIA
スクリーン衝立(防炎仕様)









アジャスター脚 ※ベージュ、ブルー、ピンク、グリーンの4色からお選びいただけます。

スクリーン衝立 価格(税抜) サイズ(mm)梱包才数梱包重量
AM-631-CLA 44,300円 W900×D400×H17501.5才7kg
AM-621-CLA 44,500円 W600×D400×H1750 ▲ 6.6才6kg 仕様/フレ-ム:スチ-ルパイプ 粉体塗装 (ホワイト) 入数:1 ●アジャスタ-仕様 ※AM-621-CLAは完成品です。


スクリーン衝立 価格(税抜) サイズ(mm)梱包才数梱包重量
AM-632-CLA 80,000円 W900×D400×H1750×2枚3.0才13kg
AM-622-CLA 69,200円 W600×D400×H1750×2枚 ▲ 6.6才10kg
AM-612-CLA 60,500円 W450×D400×H1750×2枚4.8才9kg 仕様/フレ-ム:スチ-ルパイプ 粉体塗装 (ホワイト) 入数:1 ●アジャスタ-仕様 ※AM-622-CLA、AM-612-CLAは完成品です。


スクリーン衝立 価格(税抜) サイズ(mm)梱包才数梱包重量
AM-633-CLA 112,900円 W900×D400×H1750×3枚4.5才20kg
AM-623-CLA 94,500円 W600×D400×H1750×3枚 ▲ 6.6才14kg
AM-613-CLA 84,700円 W450×D400×H1750×3枚4.8才12kg 仕様/フレ-ム:スチ-ルパイプ 粉体塗装 (ホワイト) 入数:1 ●アジャスタ-仕様 ※AM-623-CLA、AM-613-CLAは完成品です。


スクリーン衝立 価格(税抜) サイズ(mm)梱包才数梱包重量
AM-664-CLA 108,400円 W450×D400×H1750×4枚4.8才16kg 仕様/フレ-ム:スチ-ルパイプ 粉体塗装 (ホワイト)
入数:1 ●アジャスタ-仕様
グリーン ピンク
■カラーサンプル
ブルー ベージュ
AM-664-CLA ベージュ
AM-613-CLA ブルー
AM-632-CLA ピンク
AM-621-CLA グリーン
AM-621-CLA ベージュ
AM-632-CLA グリーン
AM-613-CLA グリーン
AM-664-CLA ピンク
AM-621-CLA
ブルー
AM-632-CLA ベージュ
AM-613-CLA ピンク
198
AM-664-CLA ブルー
キャスター脚
チェアデスク・収納パーティションテーブルレセプションロビーエクステリアアクセサリー木工
※ベージュ、ブルー、ピンク、グリーンの4色からお選びいただけます。



スクリーン衝立 価格(税抜) サイズ(mm)梱包才数梱包重量
AM-631-CL 45,600円 W900×D400×H17801.5才7kg
AM-621-CL 45,100円 W600×D400×H1780 ▲ 6.6才6kg

仕様/フレ-ム:スチ-ルパイプ 粉体塗装 (ホワイト) 入数:1 ●キャスタ-仕様 ※AM-621-CLは完成品です。


スクリーン衝立 価格(税抜) サイズ(mm)梱包才数梱包重量
AM-632-CL 82,600円 W900×D400×H1780×2枚3.0才13kg
AM-622-CL 70,900円 W600×D400×H1780×2枚 ▲ 6.6才10kg
AM-612-CL 61,300円 W450×D400×H1780×2枚4.8才9kg 仕様/フレ-ム:スチ-ルパイプ 粉体塗装 (ホワイト) 入数:1 ●キャスタ-仕様 ※AM-622-CL、AM-612-CLは完成品です。



スクリーン衝立 価格(税抜) サイズ(mm)梱包才数梱包重量
AM-633-CL 119,000円 W900×D400×H1780×3枚4.5才20kg
AM-623-CL 97,100円 W600×D400×H1780×3枚 ▲ 6.6才14kg
AM-613-CL 85,900円 W450×D400×H1780×3枚4.8才12kg 仕様/フレ-ム:スチ-ルパイプ 粉体塗装 (ホワイト) 入数:1 ●キャスタ-仕様 ※AM-623-CL、AM-613-CLは完成品です。


幼保レンタル・リース

スクリーン衝立 価格(税抜) サイズ(mm)梱包才数梱包重量
AM-664-CL 110,700円 W450×D400×H1780×4枚4.8才16kg 仕様/フレ-ム:スチ-ルパイプ 粉体塗装 (ホワイト) 入数:1 ●キャスタ-仕様
AM-664-CL ピンク
AM-613-CL ベージュ
AM-622-CL ライトグリーン
AM-631-CL ブルー
AM-631-CL ピンク
AM-622-CL ブルー
AM-613-CL ブルー
AM-664-CL グリーン
AM-631-CL ベージュ
AM-622-CL ピンク
AM-613-CL グリーン
199 SOCIA
AM-664-CL ベージュ
Exterior

Accessories
Woodworking
Welfare Kindergarten

G-TN18
ASO-W2411B(MAK)
G-WBL
ASO-W2411W(NA)
PRO-4W
ASO-WC2T
200
ロビー
エクステリア
ALPHA-G(GN)
Table Reception
Lobby
アクセサリー
福祉
レンタル・リース
ワークテーブル
チェアデスク・収納パーティションテーブルレセプションロビーエクステリアアクセサリー木工

ASO-W1111B (BR)






レイアウトが容易で、使い勝手が良い 奥行1100㎜の天板サイズを採用しました。
■SOCIAシリーズ天板カラーサンプル






SGR:ストーングレー WH:ホワイト NA:ナチュラル MAK:ミディアムオーク BR:ブラウン 配線ホール


ASO-W1111W (NA)
ワークテーブル 棚天板仕様価格(税抜)サイズ(mm)梱包才数梱包重量
ASO-W1111B 棚無し ABS
ASO-W1111W
114,000円 W1100×D1100×H72012.5才38.8kg
114,000円 W1100×D1100×H72012.5才38.8kg
仕様/天板:抗ウイルスメラミン化粧板 (t22mm) フラッシュ加工 抗ウイルスABSエッジ(SGRは通常ABS) 天板裏:抗ウイルスバッカ- 脚:スチール 粉体塗装(B・ブラック、W・ホワイト) 入数:1(3個口)

ASO-W1811B(SGR)

ASO-W1811W (BR)
ワークテーブル 棚天板仕様価格(税抜)サイズ(mm)梱包才数梱包重量
ASO-W1811B
ASO-W1811W
棚無し ABS
147,000円 W1800×D1100×H720 ▲ 14.3才49.9kg
147,000円 W1800×D1100×H720 ▲ 14.3才49.9kg
仕様/天板:抗ウイルスメラミン化粧板 (t22mm) フラッシュ加工 抗ウイルスABSエッジ(SGRは通常ABS) 天板裏:抗ウイルスバッカ- 脚:スチール 粉体塗装(B・ブラック、W・ホワイト) 入数:1(3個口)

ASO-W2411B (MAK)

ASO-W2411W (NA)
ワークテーブル 棚天板仕様価格(税抜)サイズ(mm)梱包才数梱包重量
ASO-W2411B 棚無し ABS
ASO-W2411W
170,000円 W2400×D1100×H72012.9才62.3kg
170,000円 W2400×D1100×H72012.9才62.3kg
仕様/天板:抗ウイルスメラミン化粧板 (t22mm) フラッシュ加工 抗ウイルスABSエッジ(SGRは通常ABS) 天板裏:抗ウイルスバッカ- 脚:スチール 粉体塗装(B・ブラック、W・ホワイト) 入数:1(4個口)

ASO-W1111W (WH)
ASO-W1111B/W

ASO-W1811W (NA)
ASO-W1811B/W

幼保レンタル・リース
ASO-W2411W (WH)
637 878 1100 1100 840 720 656 637 878 1100 1800 1540 720 656 637 878 1100 2400 2140 720 656
ASO-W2411B/W
201 SOCIA
ハイワークテーブル

ASO-WH(黒フレーム)


ワークテーブル 棚天板仕様価格(税抜)





■SOCIAシリーズ天板カラーサンプル

BR:ブラウン


WH:ホワイト NA:ナチュラル MAK:ミディアムオーク


SGR:ストーングレー


サイズ(mm)梱包才数梱包重量 ASO-WH1811B 棚付き ABS 203,000円 W1800×D1100×H1000 ▲ 15.7才66.6kg 仕様/天板:抗ウイルスメラミン化粧板 (t22mm) フラッシュ加工 抗ウイルスABSエッジ(SGRは通常ABS) 天板裏:抗ウイルスバッカ- 脚:スチ-ル 粉体塗装 (ブラック) 入数:1(4個口)


配線ホール

ASO-WH1811
616 758 1100 1800 1540 1000 544 500 21 8 1600 G-TN18
ASO-S9045B(BR)
ALES-CTB(BR)
ASO-WH1811B(MAK)
ASO-WH1811B(SGR)
ASO-WH1811B(BR)
ASO-WH1811B(MAK)
ASO-WH1811B(NA)
202
ASO-WH1811B(WH)
チェアデスク・収納パーティションテーブルレセプションロビーエクステリアアクセサリー木工

ASO-WH(白フレーム)





ワークテーブル 棚天板仕様価格(税抜)
サイズ(mm)梱包才数梱包重量 ASO-WH1811W 棚付き ABS 203,000円 W1800×D1100×H1000 ▲ 15.7才66.6kg 仕様/天板:抗ウイルスメラミン化粧板 (t22mm) フラッシュ加工 抗ウイルスABSエッジ(SGRは通常ABS) 天板裏:抗ウイルスバッカ- 脚:スチ-ル 粉体塗装 (ホワイト) 入数:1(4個口)


幼保レンタル・リース
616 758 1100 1800 1540 1000 544 500 21 8 1600 SMP-1509AR
ASO-L03W(LGN)
ALES-CT(NA)
ASO-L01W(PK)
ASO-WH1811W(NA)
ASO-WH1811
配線ホール
ASO-WH1811W(SGR)
ASO-WH1811W(BR)
ASO-WH1811W(MAK)
ASO-WH1811W(NA)
203 SOCIA
ASO-WH1811W(WH)
ワークテーブル

FDC W2400mm
■カラーサンプル
















ワークテーブル 棚天板仕様価格(税抜)サイズ(mm)梱包才数梱包重量 FDC-2412B 棚無し ABS 122,000円 W2400×D1200×H720 ▲ 7.6才67kg
FDC-2412W 122,000円 W2400×D1200×H720 ▲ 7.6才67kg
仕様/天板:パ-ティクルボ-ド メラミン化粧板 エッジ:ABS フレ-ム:スチ-ル 粉体塗装
オプションコードトレー 価格(税抜) サイズ(mm) 梱包才数 梱包重量
CDT 8,000円 W200×D107.3×H800.1才 1.5kg
仕様/本体:スチ-ル 粉体塗装 (シルバ-) 入数:1
2400 1115 1200 2280 1080 1115 720 652 400
配線ダクト 価格(税抜) サイズ(mm) 梱包才数 梱包重量 HD-790 20,000円 W126×D62×H790 0.3才 1kg 仕様/本体:ABS樹脂 (シルバ-) 入数:1
(B・ブラック、W・ホワイト) 入数:1(5個口)
FDC-1212W(WH)
ASO-OC1(GN)
FDC-2412B(NA)
チェア CK02(OR) P.080
FDC-2412B(BR)
FDC-2412W(LBR)
FDC-2412W(NA)
FDC-2412W(WH)
FDC-2412B(LBR)
配線ホール(開・閉) 使用例 CDT 配線ダクト HD-790
FDC-2412B(WH)
FDC-2412
フレーム
天板
WH:ホワイト NA:ナチュラル
LBR:ライトブラウン 204
WH:ホワイト BK:ブラック
BR:ブラウン
小規模ミーティングからフリーアドレスのオフィスまで幅広く活用できるワークデスク。
W3600mm
チェアデスク・収納パーティションテーブルレセプションロビーエクステリアアクセサリー木工






メラミン化粧板 エッジ:ABS フレ-ム:スチ-ル
W1200mm


ワークテーブル 棚天板仕様価格(税抜)サイズ(mm)梱包才数梱包重量
FDC-1212B




仕様/天板:パ-ティクルボ-ド メラミン化粧板 エッジ:ABS フレ-ム:スチ-ル 粉体塗装 (B・ブラック、W・ホ ワイト) 入数:1(3個口)
WJ インワゴン





幼保レンタル・リース
ダブルサスペンションレール ファイル収納等に便利な大型引き出し。 すべてに丈夫でスムーズに開閉する ダブルサスペンションを採用。
引出し内寸(WJ-IN2) 上・下段/W318×D487×H155(262)mm
インワゴン 価格(税抜)サイズ(mm)梱包才数梱包重量
WJ-IN2(WH) 44,000円 W395×D550×H615 6.0才24kg
WJ-IN3(WH) 44,000円 W395×D550×H615 6.0才24kg
仕様/天板:スチ-ル 粉体塗装 (ホワイト) 袖箱:スチ-ル 粉体塗装 (ホワイト) 幕板:スチ-ル 粉体塗装 (ホワイト) 入数:1 ●仕切板:(IN2) 中サイズ2枚、(IN3) 小サイズ1枚、中サイズ1枚 ●ペントレー:WJ-IN3/1個付
インワゴン 価格(税抜)サイズ(mm)梱包才数梱包重量 WJ-IN3(BK) 44,000円 W395×D550×H615 6.0才24kg
仕様/天板:スチ-ル 粉体塗装 (ブラック) 袖箱:スチ-ル 粉体塗装 (ブラック) 幕板:スチ-ル 粉体塗装 (ブラック) 入数:1 ●仕切板:小サイズ1枚、中サイズ1 枚 ●ペントレ-:1個付
引出し内寸(WJ-IN3) 上段/W318×D421×H59(107)mm 中段/W318×D421×H97(166)mm 下段/W318×D487×H155(262)mm
3600 1115 1200 3480 1080 1115 720 652 400350 1115 中野 2019.7.16 製図 1200 1080 1200 1080 720 652 ワークテーブル 棚天板仕様価格(税抜)サイズ(mm)梱包才数梱包重量 FDC-3612B 棚無し ABS 185,000円 W3600×D1200×H720 ▲ 10.4才97kg FDC-3612W 185,000円 W3600×D1200×H720 ▲ 10.4才97kg 仕様/天板:パ-ティクルボ-ド
粉体塗装
ワイト) 入数:1(8個口)
(B・ブラック、W・ホ
棚無し ABS 66,000円 W1200×D1200×H720 ▲ 3.7才35.9kg
66,000円 W1200×D1200×H720 ▲ 3.7才35.9kg
FDC-1212W
FDC-3612B(NA)
FDC-3612B(LBR)
FDC-3612B(WH)
FDC-3612W(NA)
FDC-3612W(BR)
FDC-3612W(WH)
FDC-3612
FDC-1212W(WH)
FDC-1212B(NA)
FDC-1212B(LBR)
FDC-1212B(BR)
FDC-1212W(NA)
FDC-1212W(LBR)
WJ-IN2(WH) WJ-IN3(WH)
WJ-IN3(BK)
ペントレー インワゴン3段の最上段には、 ペントレーが付属しています。
205 SOCIA
FDC-1212


角型・楕円型・舟型の3種類の天板形状で、 メッキ脚の高級感のある大型会議テーブル。
SOCIA G-MS18 P.070
チェア MG-140L P.096
NOTD-2412(NA)
P.096
チェア MG-140H
チェア MG-140L P.096
NOTK-2412(WT)
大型会議テーブル 206
大型会議テーブル
チェアデスク・収納パーティションテーブルレセプションロビーエクステリアアクセサリー木工
NOTK-2412/1890
NOTK-3612
NOTD-2412/1890
配線ダクト

WT:ウォールナット NA:ナチュラル MAK:ミディアムオーク AK:オーク ■天板色




角型


オプション配線ホール(開・閉) ※配線ホール付天板は別途 お見積り致します。

NOTK-2412(NA)
大型会議テーブル (角型) 棚天板仕様価格(税抜)サイズ(mm)梱包才数梱包重量
NOTK-3612
NOTK-2412 268,000円 W2400×D1200×H70011.8才 64kg
棚無し ABS 540,000円 W3600×D1200×H700 ▲ 17.3才98kg
NOTK-1890 145,000円 W1800×D900×H700 ▲ 6.4才 ▲ 36kg
仕様/天板:メラミン化粧板 (t30mm) (ABS樹脂巻エッジ) 脚:スチ-ル (φ50mm) クロ-ムメッキ 入数:3612:1(4個口)、2412:1(3個 口)、1890:1(1個口) ●3612サイズと2412サイズは天板が2分割仕様になります。
楕円型

大型会議テーブル (楕円型)
NOTD-3612
NOTD-2412
NOTD-1890
NOTD-2412(MAK)
棚天板仕様価格(税抜)サイズ(mm)梱包才数梱包重量
棚無し ABS
595,000円 W3600×D1200×H700 ▲ 17.3才94kg
294,000円 W2400×D1200×H70011.8才 59kg
161,000円 W1800×D900×H700 ▲ 6.4才 ▲ 30kg
仕様/天板:メラミン化粧板 (t30mm) (ABS樹脂巻エッジ) 脚:スチ-ル (φ50mm) クロ-ムメッキ 入数:3612:1(4個口)、2412:1(3個 口)、1890:1(1個口) ●3612サイズと2412サイズは天板が2分割仕様になります。
舟型

NOTF-3612(AK)
大型会議テーブル (舟型) 棚天板仕様価格(税抜)サイズ(mm)梱包才数梱包重量
NOTF-3612
NOTF-2412
NOTF-1890
棚無し ABS 595,000円 W3600×D1200×H700 ▲ 17.3才96.2kg
294,000円 W2400×D1200×H70011.8才 61kg
161,000円 W1800×D900×H700 ▲ 6.4才 ▲ 32kg
仕様/天板:メラミン化粧板 (t30mm) (ABS樹脂巻エッジ) 脚:スチ-ル (φ50mm) クロ-ムメッキ 入数:3612:1(4個口)、2412:1(3個 口)、1890:1(1個口) ●3612サイズと2412サイズは天板が2分割仕様になります。
配線ダクト 価格(税抜)サイズ(mm)梱包才数梱包重量 HD-790 20,000円 W126×D62×H7900.3才 1kg
仕様/本体:ABS樹脂 (シルバ-) 入数:1
810/590 620 2400/1800 1990/1290 1200/900 700 810 620 1470 3600 1470 1200 700 810/590 620 2400/1800 1790/1290 1200/900 700 810 620 1470 3600 1470 1200 700 810/590 620 2400/1800 1990/1290 1200/900 700 810 620 1470 3600 1470 1200 700
[角型]
NOTD-3612 [楕円型]
HD-790 配線ダクト
NOTF-3612 [舟型]
NOTF-2412/1890
207 SOCIA
幼保レンタル・リース
ミーティングテーブル






パーティション PSA-1507A(PIV)
モニターやホワイトボードを使用した打ち合わせ、 プレゼン等に最適な台形ミーティングテーブル。
正面からの位置をずらして座ることで死角が少なくなり、参加者全員が見えやすくなります。
ASO-DT
■SOCIAシリーズ天板カラーサンプル









ミーティングテーブル
ASO-DT1590B
ASO-DT1290B
棚
天板仕様価格(税抜)サイズ(mm)梱包才数梱包重量
棚無し ABS
170,000円 W1500×D900×H7204.8才 48.4kg
165,000円 W1200×D900×H7204.6才 39.4kg
仕様/天板:抗ウイルスメラミン化粧板 (t22mm) 抗ウイルスABSエッジ(SGRは通常ABS) 天板裏:抗ウイルスバッカ- 本体:メラミン化粧板 脚:スチ-ル 粉体塗装 (ブラック) 入数:1(3個口)
400 900 698 750 720 1200/1500 300/500 750 900
P.167
パーティション PSA-1512A(PIV) P.167
ロビー RO-S1200(FBJ) P.256
パーティション PSA-F P.168
ASO-DT1290B (MAK)
ASO-DT1290B(BR)
ASO-DT1290B(MAK)
ASO-DT1290B(NA)
ASO-DT1290B/ASO-DT1590B
ASO-DT1290B(WH)
WH:ホワイト NA:ナチュラル MAK:ミディアムオーク
BR:ブラウン
SGR:ストーングレー
208
ミーティングテーブル
ASO-S9045B(MAK)
チェアデスク・収納パーティションテーブルレセプションロビーエクステリアアクセサリー木工

ASO-M1890B(BR)
ASO-OC1(GN)






多彩な使い方が可能な 4本ワイド脚のシャープなミーティングテーブルです。


ASO-M1575B(NA)
ミーティングテーブル 棚天板仕様価格(税抜)サイズ(mm)梱包才数梱包重量
ASO-M1575B 棚無し ABS 88,000円 W1500×D750×H720 5.7才28.9kg
仕様/天板:抗ウイルスメラミン化粧板 (t22mm) フラッシュ加工 抗ウイルスABSエッジ(SGRは通常ABS) 天板裏: 抗ウイルスバッカ- 脚:スチ-ル 粉体塗装 (ブラック) 入数:1(3個口)


ASO-M1890B(WH)
ミーティングテーブル 棚天板仕様価格(税抜)サイズ(mm)梱包才数梱包重量
ASO-M1890B 棚無し ABS 98,000円 W1800×D900×H720 ▲ 7.0才33.9kg
仕様/天板:抗ウイルスメラミン化粧板 (t22mm) フラッシュ加工 抗ウイルスABSエッジ(SGRは通常ABS) 天板裏: 抗ウイルスバッカ- 脚:スチ-ル 粉体塗装 (ブラック) 入数:1(3個口)



ASO-M1890/1575

ASO-M1575W(SGR)
ミーティングテーブル 棚天板仕様価格(税抜)サイズ(mm)梱包才数梱包重量 ASO-M1575W 棚無し ABS 88,000円 W1500×D750×H720 5.7才28.9kg
仕様/天板:抗ウイルスメラミン化粧板 (t22mm) フラッシュ加工 抗ウイルスABSエッジ(SGRは通常ABS) 天板裏: 抗ウイルスバッカ- 脚:スチ-ル 粉体塗装 (ホワイト) 入数:1(3個口)


幼保レンタル・リース
ミーティングテーブル 棚天板仕様価格(税抜)サイズ(mm)梱包才数梱包重量
ASO-M1890W 棚無し ABS 98,000円 W1800×D900×H720 ▲ 7.0才33.9kg
仕様/天板:抗ウイルスメラミン化粧板 (t22mm) フラッシュ加工 抗ウイルスABSエッジ(SGRは通常ABS) 天板裏: 抗ウイルスバッカ- 脚:スチ-ル 粉体塗装 (ホワイト) 入数:1(3個口)
ASO-M1890/1575
657 828/678 900/750 1800/1500 1728/1428 720 657 828/678 900/750 1800/1500 1728/1428 720
ASO-M1890W(NA)
ASO-OC1 (GR)
ASO-M1890B(BR)
ASO-M1890B(SGR)
ASO-M1575W(MAK)
ASO-M1890W(BR)
ASO-M1890W(NA)
ASO-M1890W(WH)
209 SOCIA
ASO-M1575B(MAK)
ミーティングテーブル

脚間寸法が広く、適度な間隔でイスが設置できます。
TA VTA
NA:ナチュラル ■天板色
■抗ウイルス 天板カラーサンプル



WT:ウォールナット WH:ホワイト


ミーティング テーブル 棚天板仕様価格(税抜)サイズ(mm)梱包才数梱包重量
TA-2190B
TA-1890B
TA-1575B
棚無し ABS
134,000円 W2100×D900×H700 ▲ 9.7才27.6kg
100,000円 W1800×D900×H700 ▲ 8.4才23.3kg
88,000円 W1500×D750×H7005.9才18.6kg
仕様/天板:メラミン化粧板 (t21mm) フラッシュ加工 ABSエッジ 脚:スチ-ル メラミン焼付塗装 (ブラック) 入数:1 ●W2100脚間内寸:W2020×D860、W1800脚間内寸:W1720×D860、W1500脚間内寸:W1420 ×D710

BR:ブラウン


WH:ホワイト NA:ナチュラル DBR:ダークブラウン




VTA-2190B
VTA-1890B
VTA-1575B
棚無し ABS




抗ウイルスミー ティングテーブル 棚天板仕様価格(税抜)サイズ(mm)梱包才数梱包重量
165,000円 W2100×D900×H700 ▲ 9.7才27.6kg
130,000円 W1800×D900×H700 ▲ 8.4才23.3kg
120,000円 W1500×D750×H7005.9才18.6kg
仕様/天板:抗ウイルスメラミン化粧板 (t21mm) フラッシュ加工 抗ウイルスABSエッジ 天板裏:抗ウイルスバッカ- 脚:スチ-ル メラミン焼付塗装 (ブラック) 入数:1 ●W2100脚間内寸:W2020×D860、W1800脚間内寸:W1720 ×D860、W1500脚間内寸:W1420×D710
860 700 900 2100 2020 639 860 700 900 1800 1720 639 710 700 750 1500 1420 639
チェア PLC-120L P.097
SOCIA ASO-S9045B(BR) P.065
TA-2190B(WT)
TA-2190B(NA)
VTA-1890B(WH)
TA-1575B(WT)
TA/VTA-1575 210
VTA-1575B(DBR)
TA/VTA-2190 TA/VTA-1890
抗ウイルス テーブル
チェアデスク・収納パーティションテーブルレセプションロビーエクステリアアクセサリー木工

■天板色







BA-Vシリーズ
天板とエッジに抗ウイルス加工・天板裏は 抗菌加工がされた多目的テーブル。







角脚/共張りエッジ
抗ウイルステーブル 棚天板仕様価格(税抜)サイズ(mm)梱包才数梱包重量
BA-1KV
BA-2KV
BA-3KV
BA-4KV
BA-5KV
BA-6KV
BA-7KV
棚無し 共張り
59,000円 W1800×D450×H7003.9才15kg
77,000円 W1800×D600×H7005.2才19kg
86,000円 W1800×D750×H700 ▲ 6.5才22kg
88,000円 W1800×D900×H700 ▲ 7.7才27kg
77,000円 W1200×D750×H7004.3才19kg
61,000円 W900×D900×H7003.9才16kg
77,000円 W1500×D750×H7005.3才15kg 仕様/天板:抗ウイルスメラミン化粧板 (t28mm) フラッシュ加工 エッジ:共張り (抗ウイルス) 天板裏:抗菌コ-ト紙 脚:スチ-ル (〼31mm) クロ-ムメッキ 入数:1
角脚/ABSエッジ
抗ウイルステーブル 棚天板仕様価格(税抜)サイズ(mm)梱包才数梱包重量 BA-A1KV
BA-A2KV
▲ 6.5才22kg
抗ウイルステーブル 棚天板仕様価格(税抜)サイズ(mm)梱包才数梱包重量
BA-1MV
BA-2MV
BA-3MV
BA-4MV
BA-5MV
BA-6MV
BA-7MV
棚無し 共張り
円 W1800×D450×H7003.9才15kg
円 W1800×D600×H7005.2才19kg
円 W1800×D750×H700 ▲ 6.5才22kg
円 W1800×D900×H700 ▲ 7.7才27kg
74,000円 W1200×D750×H7004.3才19kg
58,000円 W900×D900×H7003.9才16kg
76,000円 W1500×D750×H7005.3才15kg
仕様/天板:抗ウイルスメラミン化粧板 (t28mm) フラッシュ加工 エッジ:共張り (抗ウイルス) 天板裏:抗菌コ-ト紙 脚:スチ-ル (〼31mm) クロ-ムメッキ 入数:1
丸脚/ABSエッジ
抗ウイルステーブル 棚天板仕様価格(税抜)サイズ(mm)梱包才数梱包重量
BA-A1MV
BA-A2MV
BA-A3MV
幼保レンタル・リース
67,000円 W1800×D450×H7003.9才15kg
円 W1800×D600×H7005.2才19kg
円 W1800×D750×H700 ▲ 6.5才22kg
棚無し
BA-A4KV 95,000円 W1800×D900×H700 ▲ 7.7才27kg
BA-A5KV 83,000円 W1200×D750×H7004.3才19kg
BA-A6KV 68,000円 W900×D900×H7003.9才16kg
BA-A7KV 89,000円 W1500×D750×H7005.3才15kg
仕様/天板:抗ウイルスメラミン化粧板 (t28mm) フラッシュ加工 エッジ:抗ウイルスABSエッジ(ピンク・グリー ンは、ホワイトのABSエッジになります。) 天板裏:抗ウイルスバッカ- 脚:スチ-ル (〼31mm) クロ-ムメッキ 入数:1
BA-A4MV
棚無し ABS
円 W1800×D900×H700 ▲ 7.7才27kg
BA-A5MV 80,000円 W1200×D750×H7004.3才19kg
BA-A6MV
BA-A7MV
66,700円 W900×D900×H7003.9才16kg
87,900円 W1500×D750×H7005.3才15kg
仕様/天板:抗ウイルスメラミン化粧板 (t28mm) フラッシュ加工 エッジ:抗ウイルスABSエッジ(ピンク・グリー ンは、ホワイトのABSエッジになります。) 天板裏:抗ウイルスバッカ- 脚:スチ-ル (〼31mm) クロ-ムメッキ 入数:1
56,000
71,000
80,000
83,000
ABS 67,000円 W1800×D450×H7003.9才15kg
85,000円 W1800×D600×H7005.2才19kg
91,000円 W1800×D750×H700
BA-A3KV
84,200
90,000
94,000
丸脚/共張りエッジ
BA-3KV(NA)
BA-3KV(WH)
角脚 丸脚
BA-3KV(DBR)
BA-3KV(BR)
BA-3KV(PK)
BA-3KV(GN)
BA-3KV(MAK)
DBR:ダークブラウン
BR:ブラウン NA:ナチュラル WH:ホワイト PK:ピンク GN:グリーン MAK:ミディアムオーク
211 SOCIA
抗ウイルス 会議テーブル

VKS
チェア
SFIDA-C1(OR) P.106
VKS-D1890(WH)
チェア
SFIDA-C1(GN) P.106
角型


抗ウイルス会議 テーブル (角型) 棚天板仕様価格(税抜)サイズ(mm)梱包才数梱包重量
VKS-1890
VKS-1875
VKS-1575
VKS-1275
VKS-1260
棚無し ABS
128,000円 W1800×D900×H700 ▲ 5.0才29kg
120,000円 W1800×D750×H700 ▲ 4.0才27kg
117,000円 W1500×D750×H7003.6才24kg
101,000円 W1200×D750×H7003.3才20kg
94,000円 W1200×D600×H7003.0才19kg
仕様/天板:抗ウイルスメラミン化粧板 (t28mm) 抗ウイルスABSエッジ 天板裏:抗ウイルスバッカ- 脚部:スチ -ル 楕円パイプ (76.5×32mm) (シルバ-塗装) 脚:スチ-ル (φ50.8mm) 塗装 (シルバ-) 入数:1(3個口) ●1890脚間内寸:W1291×D800、1875脚間内寸:W1291×D580、1575脚間内寸:W1041×D580、1275・ 1260脚間内寸:W741×D580







WH:ホワイト NA:ナチュラル DBR:ダークブラウン BR:ブラウン ■抗ウイルス 天板カラーサンプル



楕円型


抗ウイルス会議 テーブル (楕円型) 棚天板仕様価格(税抜)サイズ(mm)梱包才数梱包重量
VKS-D1890 棚無し ABS 130,000円 W1500×D750×H7003.6才24kg
VKS-D1575
120,000円 W1800×D900×H700 ▲ 5.0才29kg
仕様/天板:抗ウイルスメラミン化粧板 (t28mm) 抗ウイルスABSエッジ 天板裏:抗ウイルスバッカ- 脚部:スチ -ル 楕円パイプ (76.5×32mm) (シルバ-塗装) 脚:スチ-ル (φ50.8mm) 塗装 (シルバ-) 入数:1(3個口) ●1890脚間内寸:W1291×D800、1575脚間内寸:W1041×D580
VKS-D1890/D1575
VKS-1890/1875/1575/1275/1260
900/750/600 700 1291/1041/741 1800/1500/1200 595 800/580/580 900/750 700 1041/741 1800/1500 595 800/580
VKS-1890(NA)
VKS-D1890(BR)
VKS-1890(WH)
VKS-D1890(DBR)
212
跳ね上げ式会議テーブル
チェアデスク・収納パーティションテーブルレセプションロビーエクステリアアクセサリー木工

■天板色

NA:ナチュラル AK:オーク


IV:アイボリー


跳ね上げ式会議テーブル (シルバー塗装) AHK-1890S(AK)
跳ね上げ式会議テーブル (ダークグレー塗装) 棚天板仕様価格(税抜)サイズ(mm)梱包才数梱包重量
AHK-1890(AK)
AHK-1890(IV/NA)
AHK-1875(AK)
AHK-1875(IV/NA)
棚無し ソフトエッジ
141,000円 W1800×D750×H700 ▲ 9.1才32kg
118,000円 W1800×D750×H700 ▲ 9.1才32kg
仕様/天板:メラミン化粧板 (t28mm) 脚:スチ-ル 粉体塗装 入数:1(2個口) ●1890脚間内寸:W1690 ×D790、1875脚間内寸:W1690×D710 ●キャスター:ストッパー付2個、ストッパー無2個 ●跳ね上げ時:D750の場合H1072mm、D900の場合H1147mm
共通項目


AHK/VAHK
■抗ウイルス 天板カラーサンプル

BR:ブラウン



WH:ホワイト NA:ナチュラル DBR:ダークブラウン



抗ウイルスソフトエッジ (自社開発ソフトエッジ)



抗ウイルス跳ね上げ式会議 テーブル (ダークグレー塗装)
VAHK-1890
VAHK-1875
抗ウイルス跳ね上げ式会議 テーブル (シルバー塗装) 棚天板仕様価格(税抜)サイズ(mm)梱包才数梱包重量
VAHK-1890S 棚無し ソフトエッジ
VAHK-1875S
146,000円 W1800×D900×H700 ▲ 10.0才 ▲ 36kg
141,000円 W1800×D750×H700 ▲ 9.1才 ▲ 32kg
仕様/天板:抗ウイルスメラミン化粧板 (t28mm) 抗ウイルスソフトエッジ 天板裏:抗ウイルスバッカ- 脚:スチ-ル 粉体塗装 入数:1(2個口) ●1890脚間内寸:W1690×D790、1875脚間内寸:W1690×D710 ●キャスタ-:ストッパ-付2個、ストッパ-無2個 ●跳ね上げ時:D750の場合H1072mm、D900の場合 H1147mm
幼保レンタル・リース
AHK-1890/1875
VAHK-1890/1875
582 790/ 710138 114 7/ 1072 790/ 710 1800 1687 700 900/ 750 跳ね上げ/スタッキング
棚無し ソフトエッジ 148,000円 W1800×D900×H700 ▲ 10.0才36kg AHK-1890S(IV/NA) 123,000円 W1800×D900×H700 ▲ 10.0才36kg AHK-1875S(AK) 141,000円 W1800×D750×H700 ▲ 9.1才32kg
118,000円 W1800×D750×H700 ▲ 9.1才32kg
AHK-1875S(IV/NA)
円 W1800×D900×H700 ▲ 10.0才36kg
148,000
123,000円 W1800×D900×H700 ▲ 10.0才36kg
SFIDA(GN)
AHK-1890S(NA)
対面式 跳ね上げ
AHK-1890S(IV)
VAHK-1890S(WH)
AHK-1890(AK)
VAHK-1890(NA)
VAHK-1875(BR)
213 SOCIA
跳ね上げ式会議テーブル

チェア EL-4B-HS-BK P.104
SHM



IV:アイボリー AK:オーク ■天板色






跳ね上げ式会議 テーブル (幕板付き) 棚天板仕様価格(税抜)サイズ(mm) 梱包才数梱包重量
SHM-JM1860(AK)
SHM-JM1860(IV/NA)
SHM-JM1845(AK)
SHM-JM1845(IV/NA)
SHM-JM1560(AK)
SHM-JM1560(IV/NA)
SHM-JM1545(AK)
仕様/天板:メラミン化粧板 (t28mm) 脚:スチ-ル (φ42.7mm) メラミン焼付塗装 (ライトグレ-) 入数:1 ●脚間内寸:1890/W1690×D589、1845/W1690×D444、1560/W1390×D589、1545/W1390×D444 ●跳ね上げ時:D600の場合H1073mm、D450の場合H966mm ●キャスタ-:ストッパ-付2個、ストッパ-無2個
SHM-JM1545(IV/NA)
棚付き ソフトエッジ
135,000円 W1800×D600×H700 ▲ 7.2才26kg
円 W1800×D450×H700 ▲ 5.5才21kg
130,000円 W1500×D600×H700 6.0才21kg
102,000円 W1500×D600×H700 6.0才21kg
115,000円 W1500×D450×H700 4.6才18kg
92,000円 W1500×D450×H700 4.6才18kg 仕様/天板:メラミン化粧板 (t28mm) 脚:スチ-ル (φ42.7mm) メラミン焼付塗装 (ライトグレ-) 幕板:樹脂成型品 (グレ-) 入数:1 ●脚間内寸:1890/W1690×D589、1845/W1690×D444、1560/ W1390×D589、1545/W1390×D444 ●跳ね上げ時:D600の場合H1073mm、D450の場合H966mm ●キャスタ-:ストッパ-付2個、ストッパ-無2個


120mm 589/ 444 600/ 450 1800/ 1500 1690/ 1390 1776/ 1476 588 107 3/ 966 700 45 290 589/ 444 126 跳ね上げ/スタッキング 跳ね上げ式会議 テーブル 棚天板仕様価格(税抜)サイズ(mm) 梱包才数梱包重量 SHM-1860(AK) 棚付き ソフトエッジ 128,000円 W1800×D600×H700 ▲ 5.8才25kg SHM-1860(IV/NA) 100,000円 W1800×D600×H700 ▲ 5.8才25kg SHM-1845(AK) 112,000円 W1800×D450×H700 ▲ 4.4才20kg SHM-1845(IV/NA) 87,000円 W1800×D450×H700 ▲ 4.4才20kg SHM-1560(AK) 125,000円 W1500×D600×H700 4.9才20kg SHM-1560(IV/NA) 97,000円 W1500×D600×H700 4.9才20kg SHM-1545(AK) 110,000円 W1500×D450×H700 3.7才17kg SHM-1545(IV/NA) 87,000円 W1500×D450×H700 3.7才17kg
107,000円 W1800×D600×H700 ▲ 7.2才26kg
119,000
円 W1800×D450×H700 ▲ 5.5才21kg
94,000
SHM-JM1860(AK)
ポイント
SHM-1860(AK)
SHM-JM1860(IV)
SHM-1845(NA)
SHM-JM1845(AK)
SHM-1560(IV)
跳ね上げ時 跳ね上げイメージ
SHM-JM1545(NA) SHM-JM
214
NA:ナチュラル
フォールディングテーブル

AHM-VH アジャスターキャスタータイプ 高さ720


AHM-1545VH





チェアデスク・収納パーティションテーブルレセプションロビーエクステリアアクセサリー木工 幼保レンタル・リース




NA:ナチュラル WH:ホワイト MAK:ミディアムオーク BR:ブラウン

■天板カラーサンプル 静音キャスター
静音性に優れ、加水分解を起こさない新 素材のアジャストキャスター、移動時のゴ ロゴロ音を大幅に軽減します。


仕様/天板:抗ウイルスメラミン化粧板 (t21mm) 抗ウイルスABSエッジ 天板裏:抗ウイルスバッカ- 脚:スチ- ル 粉体塗装 (ホワイト) キャスタ-:PU (φ50mm) 入数:1 ●脚間内寸:1860/W1592×D585、1845/ W1603×D440、1545/W1303×D440 ●天板跳ね上げ機能付 ●平行スタッキング可能 ●キャスタ-:昇 降機能付アジャスタ- (ストッパ-付2個、ストッパ-無2個)




A社
キャスター 71.2dB
弊社 キャスター 58.5dB
-12.7dB
80dB ~ バス走行音 掃除機 うるさい
60dB ~ 一般的な オフィス 気に ならない
40dB ~ ささやき 郊外の深夜 静か
抗ウイルスフォールディ ングテーブル (幕板付) 棚天板仕様価格(税抜)サイズ(mm)梱包才数梱包重量
AHM-JM1860VH
AHM-JM1845VH 118,000円 W1800×D450×H7205.6才26kg
AHM-JM1545VH
棚付き ABS 140,000円 W1800×D600×H720 ▲ 7.4才 ▲ 30kg
109,000円 W1500×D450×H7204.7才19kg
仕様/天板:抗ウイルスメラミン化粧板 (t21mm) 抗ウイルスABSエッジ 天板裏:抗ウイルスバッカ- 脚:スチ -ル 粉体塗装 (ホワイト) キャスタ-:PU (φ50mm) 幕板:樹脂成型品 (グレ-) 入数:1 ●脚間内寸: 1860/W1592×D585、1845/W1603×D440、1545/W1303×D440 ●天板跳ね上げ機能付 ●平行ス タッキング可能 ●キャスタ-:昇降機能付アジャスタ- (ストッパ-付2個、ストッパ-無2個)
AHM-1860VH
AHM-1845VH/1545VH
AHM-JM1845VH/JM1545VH
45 585 610 124 585 600 1800 1592(後脚間) 1700(前脚間) 720 跳ね上げ/スタッキング 45 440 610 720 124 440 450 1800/ 1500 1603/ 1303 (後脚間) 1700/ 1400 (前脚間) 跳ね上げ/スタッキング 45 585 610 124 585 600 1800 1592(後脚間) 1700(前脚間) 720 332 跳ね上げ/スタッキング 32945 440 610 720 124 1800/ 1500 1603/ 1303 (後脚間) 1700/ 1400 (前脚間) 440 450 跳ね上げ/スタッキング 抗ウイルスフォール ディングテーブル 棚天板仕様価格(税抜)サイズ(mm)梱包才数梱包重量 AHM-1860VH 棚付き ABS 132,000円 W1800×D600×H720 ▲ 6.0才29kg AHM-1845VH 111,700円 W1800×D450×H7204.6才25kg
108,000
W1500×D450×H7203.9才18kg
円
AHM-JM1860VH(MAK)
棚付
天板跳ね上げ 平行スタッキング
AHM-JM1860VH
アジャスター機能付キャスター キャスターにはアジャスター 機能も備わっており、最大で 10㎜の微調整が可能です。
AHM-1845VH(BR)
AHM-1845VH(WH)
AHM-JM1845VH(MAK)
215 SOCIA
AHM-JM1845VH(NA)
跳ね上げ式会議テーブル

AHM


跳ね上げ式会議 テーブル 棚天板仕様価格(税抜)サイズ(mm)梱包才数梱包重量
AHM-1860
AHM-1845
AHM-1545
棚付き ソフトエッジ
97,500円 W1800×D600×H700 ▲ 6.0才27.8kg
87,000円 W1800×D450×H7004.6才24.3kg
83,000円 W1500×D450×H7003.9才17kg 仕様/天板:メラミン化粧板 (t28mm) フレ-ム:スチ-ル 粉体塗装 (シルバ-) 入数:1 ●脚間内寸:1860/ W1592×D585、1845/W1603×D440、1545/W1303×D440 ●天板跳ね上げ機能付 ●平行スタッキング 可能 ●跳ね上げ時:1860/H1069mm、1845・1545/H962mm ●キャスタ-:ストッパ-付2個、ストッパ-無 2個
平行スタッキング収納例

平行スタッキングができるので収納に スペースを取りません。

AHMは全機種、棚付です。
チェア EL-6B-ZR-BL P.101
AHM-1845(IV)



NA:ナチュラル IV:アイボリー ■天板色



跳ね上げ式会議テー ブル (幕板付き) 棚天板仕様価格(税抜)サイズ(mm)梱包才数梱包重量
AHM-JM1860
AHM-JM1845
AHM-JM1545
棚付き ソフトエッジ
104,000円 W1800×D600×H700 ▲ 7.4才28.8kg
93,600円 W1800×D450×H7005.6才25.3kg
83,700円 W1500×D450×H7004.7才18kg 仕様/天板:メラミン化粧板 (t28mm) フレ-ム:スチ-ル 粉体塗装 (シルバ-) 幕板:樹脂成型品 (グ レ-) 入数:1 ●脚間内寸:1860/W1592×D585、1845/W1603×D440、1545/W1303× D440 ●天板跳ね上げ機能付 ●平行スタッキング可能 ●跳ね上げ時:1860/H1069mm、1845・ 1545/H962mm ●キャスタ-:ストッパ-付2個、ストッパ-無2個
AHM-1845 AHM-1545
AHM-JM1845 AHM-JM1545
AHM-JM1860
130mm 45 440 450 1800/ 1500 1603/ 1303 (後脚間) 1700/ 1400 (前脚間) 580 700 440 130 跳ね上げ/スタッキング 585 585 600 1800 580 700 130 45 1592(後脚間) 1700(前脚間) 跳ね上げ/スタッキング 585 585 600 1800 1592(後脚間) 1700(前脚間) 580 700 130 45 300 跳ね上げ/スタッキング 300 45 440 450 1800/ 1500 580 700 440 130 1603/ 1303 (後脚間) 1700/ 1400 (前脚間)
AHM-1860(NA)
AHM-JM1860(IV)
AHM-1545(IV)
AHM-7550(NA)
AHM-1545(NA)
AHM-7550(IV)
AHM-1860
216
抗ウイルス跳ね上げテーブル
天板が表面・側面・裏面ともに抗ウイルス仕様の会議テーブル VAHM
幕なし 幕付

VAHM-1845(BR)

VAHM-1845(DBR)

VAHM-1845(NA)

VAHM-1845(WH)
抗ウイルス跳ね上げ 式会議テーブル 棚天板仕様価格(税抜)サイズ(mm)梱包才数梱包重量
VAHM-1860
VAHM-1845
VAHM-1545
棚付き ソフトエッジ
120,000円 W1800×D600×H700 ▲ 6.0才27.8kg
95,000円 W1800×D450×H700 4.6才24.3kg
91,000円 W1500×D450×H700 3.9才17kg
仕様/天板:抗ウイルスメラミン化粧板 (t28mm) 抗ウイルスソフトエッジ 天板裏:抗ウイルスバッカ- 脚:スチ -ル 粉体塗装 (シルバ-) 入数:1 ●脚間内寸:1860/W1592×D585、1845/W1603×D440、1545/ W1303×D440 ●天板跳ね上げ機能付 ●平行スタッキング可能 ●キャスタ-:ストッパ-付2個、ストッパ- 無2個 ●跳ね上げ時:1860/H1069mm、1845・1545/H962mm






VAHM-JM1845(DBR)

VAHM-JM1845(NA)

VAHM-JM1860(BR)

VAHM-JM1860(WH)
抗ウイルス跳ね上げ式 会議テーブル (幕板付) 棚天板仕様価格(税抜)サイズ(mm)梱包才数梱包重量
VAHM-JM1860
VAHM-JM1845
VAHM-JM1545
棚付き ソフトエッジ
126,000円 W1800×D600×H700 ▲ 7.4才28.8kg
105,000円 W1800×D450×H700 5.6才25.3kg
94,000円 W1500×D450×H700 4.7才18kg
仕様/天板:抗ウイルスメラミン化粧板 (t28mm) 抗ウイルスソフトエッジ 天板裏:抗ウイルスバッカ- 脚:スチ- ル 粉体塗装 (シルバ-) 幕板:樹脂成型品 (グレ-) 入数:1 ●脚間内寸:1860/W1592×D585、1845/ W1603×D440、1545/W1303×D440 ●天板跳ね上げ機能付 ●平行スタッキング可能 ●キャスタ-: ストッパ-付2個、ストッパ-無2個 ●跳ね上げ時:1860/H1069mm、1845・1545/H962mm




抗ウイルスソフトエッジ (自社開発ソフトエッジ) 平行スタッキング 棚付
WH:ホワイト NA:ナチュラル DBR:ダークブラウン BR:ブラウン ■抗ウイルス 天板カラーサンプル
217 SOCIA
幼保レンタル・リース
チェアデスク・収納パーティションテーブルレセプションロビーエクステリアアクセサリー木工



跳ね上げ式研修 用デスク 棚天板仕様価格(税抜)サイズ(mm)梱包才数梱包重量
AHM-6545 棚付き ソフトエッジ 49,000円 W650×D450×H7001.7才11kg
仕様/天板:メラミン化粧板 (t28mm) フレ-ム:スチ-ル 粉体塗装 (シルバ-) 入数:1 ●脚間内寸:W427 ×D440 ●天板跳ね上げ機能付 ●平行スタッキング可能 ●両側フック付 ●キャスタ-:ストッパ-付2個、 ストッパ-無2個
VAHM



抗ウイルス跳ね上げ 式研修用デスク 棚天板仕様価格(税抜)サイズ(mm)梱包才数梱包重量 VAHM-6545 棚付き ソフトエッジ 53,000円 W650×D450×H7001.7才11kg
仕様/天板:抗ウイルスメラミン化粧板 (t28mm) 抗ウイルスソフトエッジ 天板裏:抗ウイルスバッカ- 脚:スチ- ル 粉体塗装 (シルバ-) 入数:1 ●脚間内寸:W427×D440 ●天板跳ね上げ機能付 ●平行スタッキング 可能 ●キャスタ-:ストッパ-付2個、ストッパ-無2個 ●両側フック付
研修用デスク AHM




跳ね上げ式研修用 デスク (幕板付き) 棚天板仕様価格(税抜)サイズ(mm)梱包才数梱包重量 AHM-JM6545 棚付き ソフトエッジ 53,000円 W650×D450×H7002.1才13kg
仕様/天板:メラミン化粧板 (t28mm) フレ-ム:スチ-ル 粉体塗装 (シルバ-) 幕板:樹脂成型品 (グレ-) 入数:1 ●脚間内寸:W427×D440 ●天板跳ね上げ機能付 ●平行スタッキング可能 ●両側フック付 ●キャスタ-:ストッパ-付2個、ストッパ-無2個





抗ウイルス跳ね上げ 式研修用デスク (幕板付)
棚天板仕様価格(税抜)サイズ(mm)梱包才数梱包重量 VAHM-JM6545 棚付きソフトエッジ 56,000円 W650×D450×H7002.1才13kg 仕様/天板:抗ウイルスメラミン化粧板 (t28mm) 抗ウイルスソフトエッジ 天板裏:抗ウイルスバッカ- 脚:スチ- ル 粉体塗装 (シルバ-) 幕板:樹脂成型品 (グレ-) 入数:1 ●脚間内寸:W427×D440 ●天板跳ね上 げ機能付 ●平行スタッキング可能 ●キャスタ-:ストッパ-付2個、ストッパ-無2個 ●両側フック付
45 440 440 450 650 580 962 700 130 427(後脚間) 524(前脚間) 跳ね上げ/スタッキング 300 45 440 440 450 650 427(後脚間) 580 962 700 130 524(前脚間) 跳ね上げ/スタッキング 45 440 440 450 650 427 582 580 962 700 130 跳ね上げ/スタッキング 300 45 440 440 450 650 427 582 580 962 700 130 跳ね上げ/スタッキング
IV:アイボリー NA:ナチュラル ■天板カラーサンプル
VAHM-6545 VAHM-JM6545
AHM-6545
WH:ホワイト NA:ナチュラル DBR:ダークブラウン BR:ブラウン ■抗ウイルス 天板カラーサンプル
AHM-JM6545
AHM-6545(IV)
VAHM-6545(BR)
AHM-6545(NA)
VAHM-6545(WH)
AHM-JM6545(IV)
VAHM-JM6545(DBR)
AHM-JM6545(IV)
218
VAHM-JM6545(NA)
研修用デスク
AHM-VH
■天板カラーサンプル




BR:ブラウン



抗ウイルスフォール ディングテーブル 棚天板仕様価格(税抜)サイズ(mm)梱包才数梱包重量
AHM-6545VH 棚付き ABS 66,500円 W650×D450×H7201.7才12kg 仕様/天板:抗ウイルスメラミン化粧板 (t21mm) 抗ウイルスABSエッジ 天板裏:抗ウイルスバッカ- 脚:スチ- ル 粉体塗装 (ホワイト) キャスタ-:PU (φ50mm) 入数:1 ●脚間内寸:W427×D440 ●天板跳ね上げ 機能付 ●平行スタッキング可能 ●キャスタ-:昇降機能付アジャスタ- (ストッパ-付2個、ストッパ-無2個) ●両 側フック付
共通項目(AHM-VH・VAHM・ AHM)

ワンタッチレバー レバーを握ることで簡単に天板を跳ね上 げ、スタッキングすることができます。
機能比較表


天板跳ね上げ平行スタッキング
天板高 H700mm
天板高 H720mm





荷掛けフック 手荷物をかけるフックが両側につ いています。耐荷重:約5kg 棚板 天板下には棚板がついており、ノートや筆記具 等を収納できます。
抗ウイルス 天板 抗ウイルス エッジ(ABS) 抗ウイルス エッジ(ソフト) 静音 キャスター 天板カラー









抗ウイルスフォールディン グテーブル (幕板付) 棚天板仕様価格(税抜)サイズ(mm)梱包才数梱包重量 AHM-JM6545VH 棚付き ABS 69,000円 W650×D450×H7202.1才14kg 仕様/天板:抗ウイルスメラミン化粧板 (t21mm) 抗ウイルスABSエッジ 天板裏:抗ウイルスバッカ- 脚:スチ -ル 粉体塗装 (ホワイト) キャスタ-:PU (φ50mm) 幕板:樹脂成型品 (グレ-) 入数:1 ●脚間内寸: W427×D440 ●天板跳ね上げ機能付 ●平行スタッキング可能 ●キャスタ-:昇降機能付アジャスタ- (ストッ パ-付2個、ストッパ-無2個) ●両側フック付
45 440 440 450 650 427(後脚間) 610 988 720 124 524(前脚間) 跳ね上げ/スタッキング 32945 440 440 450 650 427(後脚間) 610 988 720 124 524(前脚間) 跳ね上げ/スタッキング
AHM-6545VH
AHM-JM6545VH
WH:ホワイト NA:ナチュラル MAK:ミディアムオーク
AHM● IV・NA VAHM● ● ● BR・DBR・ NA・WH AHM-VH ● ● ● ● BR・MAK・ NA・WH 45 440 440 450 650 580 962 700 130 427(後脚間) 524(前脚間) 跳ね上げ/スタッキング 45 440 450 650 427(後脚間) 610 720 524(前脚間) 跳ね上げ/スタッキング ABSエッジ 抗ウイルスソフトエッジ (自社開発ソフトエッジ) 静音キャスター AHM-6545VH(NA) AHM-6545VH(WH) AHM-JM6545VH(BR) AHM-JM6545VH(MAK) 219 SOCIA チェアデスク・収納パーティションテーブルレセプションロビーエクステリアアクセサリー木工 幼保レンタル・リース
抗ウイルス 昇降テーブル

オフィスアクセサリー WBS-1209RF P.290
VLTC
W1800mm




昇降レバー レバーを握ることで天板高を無段階で昇降させること が可能です。




VLTC-L1575(NA)
天板昇降は、ガスシリンダー式を採用。
電源を必要としないためレイアウトも自由自在。
W1500mm

仕様/天板:抗ウイルスメラミン化粧板 フラッシュ加工 抗ウイルスABSエッジ 天板裏:抗ウイルスバッカ- フレ-ム:スチ-ル 粉体塗装 (ホワイト) 入数:1(2個口) ●ガスシリンダ-式天板昇降機能付

天板昇降機能イメージ
■抗ウイルス 天板カラーサンプル
昇降調整 天板高調調整のために、脚に 50mmピッチで目盛りが設けて あります。




WH:ホワイト NA:ナチュラル DBR:ダークブラウン BR:ブラウン
1500 1336 750 700 1464 720 ~ 1145 522 ~ 947 325325 1800 1636 900 800 1764 720 ~ 1145 522 ~ 947 400400 抗ウイルス昇降テー ブル 棚天板仕様価格(税抜) サイズ(mm) 梱包才数梱包重量 VLTC-L1890 棚無し ABS 173,000円 W1800×D900×H720~1150 ▲ 11.2才45.2kg VLTC-L1575 165,000円 W1500×D750×H720~1150 ▲ 9.1才39.6kg
VLTC-L1890(DBR)
VLTC-L1890
VLTC-L1575(NA)
VLTC-L1575
220
抗ウイルス会議テーブル
チェアデスク・収納パーティションテーブルレセプションロビーエクステリアアクセサリー木工

省スペースのレイアウトに適した多目的テーブル。
VKT-TN

VKT-TN6545BBSE(NA)
抗ウイルス会議テーブル (バネ脚) 棚 天板仕様 価格(税抜)サイズ(mm) 梱包才数梱包重量
VKT-TN6545BBSE 棚無し ソフトエッジ 44,000円 W650×D450×H700 1.5才10kg 仕様/天板:抗ウイルスメラミン化粧板 (t28mm) 抗ウイルスソフトエッジ 天板裏:抗ウイルスバッカ- フレ-ム: スチ-ル (〼26mm) メラミン焼付塗装 入数:1 ●バネ脚 ●折畳時:H118mm

抗ウイルス会議テーブル (バネ脚) 棚 天板仕様 価格(税抜)サイズ(mm) 梱包才数梱包重量
VKT-TN1245BBSE 棚無し ソフトエッジ 57,000円 W1200×D450×H700 2.1才14kg 仕様/天板:抗ウイルスメラミン化粧板 (t28mm) 抗ウイルスソフトエッジ 天板裏:抗ウイルスバッカ- フレ-ム: スチ-ル (〼26mm) メラミン焼付塗装 入数:1 ●バネ脚 ●折畳時:H91mm
■天板色


WH:ホワイト NA:ナチュラル

VKT-TN9045BBSE(NA)
抗ウイルス会議テーブル (バネ脚) 棚 天板仕様 価格(税抜)サイズ(mm) 梱包才数梱包重量 VKT-TN9045BBSE 棚無し ソフトエッジ 45,000円 W900×D450×H700 1.6才12kg
仕様/天板:抗ウイルスメラミン化粧板 (t28mm) 抗ウイルスソフトエッジ 天板裏:抗ウイルスバッカ- フレ-ム: スチ-ル (〼26mm) メラミン焼付塗装 入数:1 ●バネ脚 ●折畳時:H91mm



幼保レンタル・リース
スタッキング例 自社独自開発の抗ウイルスエッジ
548 650 450 282 700 646 666 118 1200/ 900 700 938/ 813 450 646 346 91
チェア SFIDA-B(BL) P.107
VKT-TN6545BBSE(NA)
VKT-TN1245BBSE(NA)
VKT-TN6545BBSE VKT-TN1245BBSE・TN9045BBSE 221 SOCIA
折り畳み会議テーブル

パーティション APF-1812FK(GN) P.193
パーティション APF-1812FK(IV) P.193
天板表面、エッジ、天板裏の全面に抗ウイルス加工が施されています。 ノートPCや本などを収納できる棚付き。
VKT








抗ウイルス折畳み会議 テーブル (シルバー塗装) 棚天板仕様価格(税抜)サイズ(mm)梱包才数梱包重量
VKT-1890S
VKT-1860S
VKT-1845S
棚付き 共張り
94,000円 W1800×D900×H700 ▲ 5.7才21kg
65,000円 W1800×D600×H7004.6才24.3kg
47,800円 W1800×D450×H7003.9才17kg
仕様/天板:抗ウイルスメラミン化粧板 (t28mm) フラッシュ加工 共張り (抗ウイルス) 天板裏:抗ウイルスバッカ- 脚:スチ-ル (〼26mm) メラミン焼付塗装 スライド脚 (折畳時:H91mm) 入数:1

抗ウイルス折畳み会議 テーブル (ブラック塗装)
VKT-1890B
VKT-1860B
VKT-1845B
棚天板仕様価格(税抜)サイズ(mm)梱包才数梱包重量
棚付き 共張り


94,000円 W1800×D900×H700 ▲ 5.7才21kg
65,000円 W1800×D600×H7004.6才24.3kg
47,800円 W1800×D450×H7003.9才17kg
仕様/天板:抗ウイルスメラミン化粧板 (t28mm) フラッシュ加工 共張り (抗ウイルス) 天板裏:抗ウイルスバッカ- 脚:スチ-ル (〼26mm) メラミン焼付塗装 スライド脚 (折畳時:H91mm) 入数:1
製図 444/ 346 600/ 450 1800 1540 700 545 91 中野 2021.10.26 2022.10.24 X 折り畳み時 82 1 76 444/ 346 600/ 450 1800 1540 700 545 91 折り畳み時 82 1 76 648 900 1800 1540 700 545 91 折り畳み時 82 2 11 648 900 1800 1540 700 545 91 折り畳み時 82 2 11
VKT-1845S(WH)
VKT-1845S(WH)
VKT-1860S(NA)
VKT-1890S(MAK)
VKT-1845B(NA)
VKT-1860B(BR)
VKT-1890B(DBR)
VKT-1890S
VKT-1890B
VKT-1860S・1845S
WH:ホワイト NA:ナチュラル MAK:ミディアムオーク DBR:ダークブラウン
222
VKT-1860B・1845B
BR:ブラウン ■天板色
折り畳み会議テーブル
YKT(スライド脚) 共張りエッジ



ソフトエッジ 共張り







折畳み会議テーブル (共張り) 棚 天板仕様価格(税抜)サイズ(mm)梱包才数梱包重量
YKT-1860
YKT-1845
YKT-1560
YKT-1890 棚付き 共張り
YKT-1545
YKT-1260
YKT-1245
72,000円 W1800×D900×H700 ▲ 6.1才 21kg
41,000円 W1800×D600×H7004.2才 18kg
35,000円 W1800×D450×H7003.2才 15kg
41,000円 W1500×D600×H7003.5才 15kg
34,000円 W1500×D450×H7002.6才 12kg
41,000円 W1200×D600×H7002.8才 12kg
33,000円 W1200×D450×H7002.1才 10kg 仕様/天板:メラミン化粧板 (t28mm) フラッシュ加工 フレ-ム:スチ-ル (〼26mm) メラミン焼付塗装 入数:1 ●スライド脚 ● (RO) (TE) の天板は黒、(IV) の 天板は白のソフトエッジになります。 ●天板が (RO) (TE) のフレ-ムカラ-はシャンパンゴ-ルド、(IV) のフレ-ムカラ-はシルバ-です。ブラックフレ-ムは別注品となりま すのでお問い合わせ下さい。 ●折畳時:H91mm




黒フレーム仕様も可能です。 ※黒フレーム仕様は別途お見積りいたします。 お気軽にお問い合わせ下さい。


折畳み会議テーブル
YKT-1260SE
39,000円 W1500×D450×H7002.6才 12kg
円 W1200×D600×H7002.8才 12kg
YKT-1245SE 39,000円 W1200×D450×H7002.1才 10kg 仕様/天板:メラミン化粧板 (t28mm) フラッシュ加工 フレ-ム:スチ-ル (〼26mm) メラミン焼付塗装 入数:1 ●スライド脚 ● (RO) (TE) の天板は黒、(IV) の 天板は白のソフトエッジになります。 ●天板が (RO) (TE) のフレ-ムカラ-はシャンパンゴ-ルド、(IV) のフレ-ムカラ-はシルバ-です。ブラックフレ-ムは別注品となりま すのでお問い合わせ下さい。 ●折畳時:H91mm
414/ 316 322 600/ 450 1200 940 700 545 91 折り畳み時 82 1 76 444/ 346 600/ 450 1800/ 1500 1540/ 1290 700 545 91 折り畳み時 82 2 11 648 900 1800 1540 700 545 91 折り畳み時 82
(ソフトエッジ) 棚 天板仕様価格(税抜)サイズ(mm)梱包才数梱包重量 YKT-1890SE 棚付き ソフトエッジ 77,000円 W1800×D900×H700 ▲ 6.1才 21kg YKT-1860SE 49,000円 W1800×D600×H7004.2才 18kg YKT-1845SE 40,000円 W1800×D450×H7003.2才 15kg YKT-1560SE 48,000円 W1500×D600×H7003.5才 15kg YKT-1545SE
48,000
ソフトエッジ
YKT-1890(TE)
YKT-1245(IV)
YKT-1860(IV)
YKT-1260(RO)
YKT-1560(RO)
YKT-1545(IV)
YKT-1890SE(RO)
YKT-1260SE(RO)
YKT-1845SE(TE)
YKT-1560SE(IV)
YKT-1860・YKT-1860SE・YKT-1845・YKT-1845SE・ YKT-1560・YKT-1560SE・YKT-1545・YKT-1545SE YKT-1260・YKT-1260SE・YKT-1245・YKT-1245SE
YKT-1890・YKT-1890SE
IV:アイボリー TE:チーク RO:ローズ ■天板色 223 SOCIA チェアデスク・収納パーティションテーブルレセプションロビーエクステリアアクセサリー木工 幼保レンタル・リース
ワイド脚テーブル
WLB(バネ脚)

WLB-1845TSE(IV)

WLB-1845TSE(RO)






WLB-1845SE(TE)

WLB-1845SE(IV)
折畳み会議テーブル 棚天板仕様価格(税抜)サイズ(mm) 梱包才数梱包重量 WLB-1860TSE
仕様/天板:メラミン化粧板 (t28mm) フラッシュ加工 フレ-ム:スチ-ル (〼26mm) メラミン焼付塗装 (ブラッ ク) 入数:1 ●バネ脚 ● (RO) (TE) の天板は黒、(IV) の天板は白のソフトエッジになります。 ●折畳時:H98mm
アルミ折り畳み会議テーブル
TU(バネ脚)

TU-1845TSE(TE)



折畳み会議テーブル 棚天板仕様価格(税抜)サイズ(mm) 梱包才数梱包重量
WLB-1860SE
WLB-1845SE
棚無し ソフトエッジ
WLB-1860 共張り
WLB-1845
折畳み会議テーブル 棚天板仕様価格(税抜)サイズ(mm) 梱包才数梱包重量 TU-1860TSE
4.2才17kg
TU-1845T
51,000円 W1800×D600×H700 4.2才19kg
45,000円 W1800×D450×H700 3.2才15kg
47,000円 W1800×D600×H700 4.2才19kg
40,000円 W1800×D450×H700 3.2才15kg
仕様/天板:メラミン化粧板 (t28mm) フラッシュ加工 フレ-ム:スチ-ル (〼26mm) メラミン焼付塗装 (ブラッ ク) 入数:1 ●バネ脚 ● (RO) (TE) の天板は黒、(IV) の天板は白のソフトエッジになります。 ●折畳時:H98mm
共張り ソフトエッジ





TU-1845SE(RO)

TU-1845(IV)
折畳み会議テーブル 棚天板仕様価格(税抜)サイズ(mm) 梱包才数梱包重量
TU-1860SE
TU-1845SE
54,000円 W1800×D450×H700 3.2才15kg
仕様/天板:メラミン化粧板 (t28mm) フラッシュ加工 フレ-ム:アルミ (〼27mm) アクリル塗装 (シルバ-) 入数:1 ●バネ脚 ● (RO) (TE) の天板は黒、(IV) の天板は白のソフトエッジになります。 ●折畳時:H91mm
棚無し ソフトエッジ
TU-1860 共張り
TU-1845
64,000円 W1800×D600×H700 4.2才13kg
54,000円 W1800×D450×H700 3.2才12kg
59,000円 W1800×D600×H700 4.2才13kg
49,000円 W1800×D450×H700 3.2才12kg
仕様/天板:メラミン化粧板 (t28mm) フラッシュ加工 フレ-ム:アルミ (〼27mm) アクリル塗装 (シルバ-) 入数:1 ●バネ脚 ● (RO) (TE) の天板は黒、(IV) の天板は白のソフトエッジになります。
●折畳時:H91mm
449/ 349 600/ 450 1800 1680 700 192 573 91 57 折り畳み時 449/ 349 600/ 450 1800 1680 700 645 91 折り畳み時 192
棚付き ソフトエッジ 67,000円 W1800×D600×H700 4.2才17kg TU-1845TSE 59,000円 W1800×D450×H700 3.2才15kg TU-1860T 共張り 62,000円 W1800×D600×H700
棚付き ソフトエッジ 56,000円 W1800×D600×H700 4.2才20kg
48,000円 W1800×D450×H700 3.2才16kg WLB-1860T 共張り 51,000円 W1800×D600×H700 4.2才20kg WLB-1845T 44,000円 W1800×D450×H700 3.2才16kg
WLB-1845TSE
棚取外し
棚取付
TU-1845T・1845TSE・TU-1860T・1860TSE TU-1845・1845SE・TU-1860・1860SE
TE:チーク RO:ローズ
IV:アイボリー TE:チーク RO:ローズ
共張り ソフトエッジ 224
IV:アイボリー
■天板色
■天板色
ワイド脚テーブル
WL(クランク脚)
チェアデスク・収納パーティションテーブルレセプションロビーエクステリアアクセサリー木工










WLシリーズは、黒フレーム仕様も可 能です。
※黒フレーム仕様は別途お見積りいたします。お 気軽にお問い合わせ下さい。
折畳み会議テーブル (ワイドワランク脚) 棚天板仕様価格(税抜)サイズ(mm) 梱包才数梱包重量
WL-1860TSE
WL-1845SE 43,000円 W1800×D450×H700 3.2才15kg
棚無し ソフトエッジ 50,000円 W1800×D600×H700 4.2才19kg
WL-1860 共張り 46,000円 W1800×D600×H700 4.2才19kg
WL-1845
38,000円 W1800×D450×H700 3.2才15kg
仕様/天板:メラミン化粧板 (t28mm) フラッシュ加工 フレ-ム:スチ-ル (〼26mm) メラミン焼付塗装 入数:1 ●クランク脚 ● (RO) (TE) の天板は黒、(IV) の天板は白のソフトエッジになります。 ●天板が (RO) (TE) のフレ-ムカラ-はシャンパンゴ-ルド、(IV) のフレ-ムカラ-はシルバ-です。 ●折畳時:H98mm
座卓兼用会議テーブル
KTZ(角脚)(クランク脚)



WL-1845TSE
WL-1845T
棚付き ソフトエッジ 54,000円 W1800×D600×H700 4.2才20kg
44,000円 W1800×D450×H700 3.2才16kg
WL-1860T 共張り 49,000円 W1800×D600×H700 4.2才20kg
39,000円 W1800×D450×H700 3.2才16kg
仕様/天板:メラミン化粧板 (t28mm) フラッシュ加工 フレ-ム:スチ-ル (〼26mm) メラミン焼付塗装 入数:1 ●クランク脚 ● (RO) (TE) の天板は黒、(IV) の天板は白のソフトエッジになります。 ●天板が (RO) (TE) のフレ-ムカラ-はシャンパンゴ-ルド、(IV) のフレ-ムカラ-はシルバ-です。 ●折畳時:H98mm





折畳み会議テーブル (座卓兼用) 棚天板仕様価格(税抜)サイズ(mm) 梱包才数梱包重量
KTZ-1860
KTZ-1845
棚無し 共張り 54,000円 W1800×D600×H700 4.2才19kg
45,900円 W1800×D450×H700 3.2才16kg 仕様/天板:メラミン化粧板 (t28mm) フラッシュ加工 フレ-ム:スチ-ル (〼26mm) メラミン焼付塗装 入数: 1 ●座卓時:1860/W1800×D600×H330、1845/W1800×D450×H330 ●テ-ブル時:クランク脚 座 卓時:バネ脚 ● (RO) (TE) の天板は黒、(IV) の天板は白のソフトエッジになります。 ●天板が (RO) (TE) の フレ-ムカラ-はシャンパンゴ-ルド、(IV) のフレ-ムカラ-はシルバ-です。 ●折畳時:H90mm
折畳み会議テーブル (座卓兼用) 棚天板仕様価格(税抜)サイズ(mm) 梱包才数梱包重量
KTZ-1860SE 棚無し ソフトエッジ 58,000円 W1800×D600×H700 4.2才19kg
KTZ-1845SE 50,000円 W1800×D450×H700 3.2才16kg
幼保レンタル・リース
仕様/天板:メラミン化粧板 (t28mm) フラッシュ加工 フレ-ム:スチ-ル (〼26mm) メラミン焼付塗装 入数: 1 ●座卓時:1860/W1800×D600×H330、1845/W1800×D450×H330 ●テ-ブル時:クランク脚 座 卓時:バネ脚 ● (RO) (TE) の天板は黒、(IV) の天板は白のソフトエッジになります。 ●天板が (RO) (TE) の フレ-ムカラ-はシャンパンゴ-ルド、(IV) のフレ-ムカラ-はシルバ-です。 ●折畳時:H90mm

黒フレーム仕様も可能です。 ※黒フレーム仕様は別途お見積りいたします。 お気軽にお問い合わせ下さい。
610 1800 1540 700 600/ 450 1800 1405 600/ 450 折り畳み時 座卓時 91 330 240 610 1800/ 1500 1540/ 1290 700 91 600/ 450 1800/ 1500 1410/ 1160 330 240 600/ 450 折り畳み時 座卓時 折畳み会議テーブル (ワイドワランク脚) 棚天板仕様価格(税抜)サイズ(mm) 梱包才数梱包重量
WL-1860SE
KTZ
WL-1845TSE(TE)
WL-1845TSE(IV)
WL-1845SE(RO)
WL-1845SE(TE)
座卓時(H330㎜)
KTZ-1845(RO)
KTZ-1845SE(TE)
KTZ-1845SE(RO)
KTZ-1845(TE)
■天板色
IV:アイボリー TE:チーク RO:ローズ
共張り ソフトエッジ 225 SOCIA
IV:アイボリー TE:チーク RO:ローズ
■天板色
座卓兼用会議テーブル
KTZ(平板脚タイプ) H700
■天板色



IV:アイボリー TE:チーク RO:ローズ

KTZ-1845HSE(TE)
KTZ-1545HSE(IV)
高脚高さH700㎜


KTZ-1845HSE(RO)
KTZ-1845H
KTZ-1560H
4.0才19kg
47,000円 W1800×D450×H700 3.2才16kg
54,000円 W1500×D600×H700 3.5才16kg
KTZ-1545H 46,000円 W1500×D450×H700 2.6才13kg
仕様/天板:メラミン化粧板 (t28mm) フラッシュ加工 フレ-ム:スチ-ル (〼26mm) メラミン焼付塗装 (ブラッ ク) 入数:1 ●テ-ブル時:クランク脚 座卓時:バネ脚 ● (RO) (TE) の天板は黒、(IV) の天板は白のソフト エッジになります。 ●座卓時:H330mm ●高脚高さ:H700mm ●折畳時:H90mm
H630 ローチェア用

KTZ-L1845HSE(IV)
高脚高さH630㎜

KTZ-L1545HSE(RO)
折畳み会議テーブル (座卓兼用) 棚 天板仕様 価格(税抜)サイズ(mm) 梱包才数梱包重量
KTZ-L1860H
KTZ-L1845H
KTZ-L1560H
KTZ-L1545H
2.6才12kg 仕様/天板:メラミン化粧板 (t28mm) フラッシュ加工 フレ-ム:スチ-ル (〼26mm) メラミン焼付塗装 (ブラッ ク) 入数:1 ●テ-ブル時:クランク脚 座卓時:バネ脚 ● (RO) (TE) の天板は黒、(IV) の天板は白のソフト エッジになります。 ●座卓時:H330mm ●高脚高さ:H630mm ●折畳時:H90mm
平板脚 平板脚

畳の上で使用しても畳を傷めません。 畳の上で使用しても畳を傷めません。

座卓時(H330㎜) 座卓時(H330㎜)

KTZ-L1845HSE(TE)


540 1800/ 1500 1540/ 1290 630 91 600/ 450 1800/ 1500 1410/ 1160 330 240 600/ 450 折り畳み時 座卓時 540 1800/ 1500 1540/ 1290 630 91 600/ 450 1800/ 1500 1410/ 1160 330 240 600/ 450 折り畳み時 座卓時 折畳み会議テーブル (座卓兼用) 棚天板仕様価格(税抜)サイズ(mm) 梱包才数梱包重量 KTZ-1860HSE 棚無し ソフトエッジ 61,500円 W1800×D600×H700 4.0才19kg KTZ-1845HSE 51,800円 W1800×D450×H700 3.2才16kg KTZ-1560HSE 60,000円 W1500×D600×H700 3.5才16kg KTZ-1545HSE 50,000円 W1500×D450×H700 2.6才13kg KTZ-1860H 共張り 55,000円 W1800×D600×H700
KTZ-L1860HSE 棚無し ソフトエッジ 61,000円 W1800×D600×H630 4.2才18kg KTZ-L1845HSE 52,000円 W1800×D450×H630 3.2才15kg KTZ-L1560HSE 60,000円 W1500×D600×H630 3.5才15kg KTZ-L1545HSE 50,000円 W1500×D450×H630 2.6才12kg
共張り 55,000円 W1800×D600×H630 4.2才18kg
50,000円 W1800×D450×H630 3.2才15kg
54,000円 W1500×D600×H630 3.5才15kg
46,000円 W1500×D450×H630
KTZ-H
KTZ-LH
226
座卓
YKZ(平板脚タイプ)
チェアデスク・収納パーティションテーブルレセプションロビーエクステリアアクセサリー木工
■天板色





畳の上で使用しても畳 を傷めません。
黒フレーム仕様も可能 です。
※黒フレーム仕様は 別途お見積りいた します。お気軽 にお問い合わせ 下さい。

YKZ-1260H
YKZ-1245H
2.6才12kg
37,000円 W1200×D600×H330 2.8才12kg
31,000円 W1200×D450×H330 2.1才10kg
仕様/天板:メラミン化粧板 (t28mm) フラッシュ加工 フレ-ム:スチ-ル (〼26mm) メラミン焼付塗装
入数:1 ●スライド脚 ●天板が (RO) (TE) のフレ-ムカラ-はシャンパンゴ-ルド、(IV) のフレ-ムカラ-は シルバ-です。 ●折畳時:H98mm
YKZ(角脚タイプ)
■天板色



折畳み座卓 (平板脚) 棚 天板仕様 価格(税抜)サイズ(mm) 梱包才数梱包重量
YKZ-1860HSE
YKZ-1845HSE
YKZ-1560HSE
YKZ-1545HSE
YKZ-1260HSE
YKZ-1245HSE
棚無し ソフトエッジ
45,000円 W1800×D600×H330 4.2才18kg
38,000円 W1800×D450×H330 3.2才15kg
44,000円 W1500×D600×H330 3.5才15kg
38,000円 W1500×D450×H330 2.6才12kg
43,000円 W1200×D600×H330 2.8才12kg
35,000円 W1200×D450×H330 2.1才10kg
仕様/天板:メラミン化粧板 (t28mm) フラッシュ加工 フレ-ム:スチ-ル (〼26mm) メラミン焼付塗装 入数:1 ●スライド脚 ●天板が (RO) (TE) のフレ-ムカラ-はシャンパンゴ-ルド、(IV) のフレ-ムカラ-は シルバ-です。 ● (RO) (TE) の天板は黒、(IV) の天板は白のソフトエッジになります。 ●折畳時:H98mm



黒フレーム仕様も可能 です。 ※黒フレーム仕様は 別途お見積りいた します。お気軽 にお問い合わせ 下さい。

折畳み座卓 棚 天板仕様 価格(税抜)サイズ(mm) 梱包才数梱包重量
YKZ-1545
YKZ-1260
YKZ-1245
3.5才15kg
30,000円 W1500×D450×H330 2.6才12kg
34,000円 W1200×D600×H330 2.8才12kg
28,000円 W1200×D450×H330 2.1才10kg
仕様/天板:メラミン化粧板 (t28mm) フラッシュ加工 フレ-ム:スチ-ル (〼26mm) メラミン焼付塗装 入数:1 ●スライド脚 ●天板が (RO) (TE) のフレ-ムカラ-はシャンパンゴ-ルド、(IV) のフレ-ムカラ-は シルバ-です。 ●折畳時:H98mm
折畳み座卓 棚 天板仕様 価格(税抜)サイズ(mm) 梱包才数梱包重量
YKZ-1860SE
YKZ-1845SE
YKZ-1560SE
YKZ-1545SE
YKZ-1260SE
YKZ-1245SE
棚無し ソフトエッジ
43,000円 W1800×D600×H330 4.2才18kg
35,000円 W1800×D450×H330 3.2才15kg
42,000円 W1500×D600×H330 3.5才15kg
35,000円 W1500×D450×H330 2.6才12kg
40,000円 W1200×D600×H330 2.8才12kg
33,000円 W1200×D450×H330 2.1才10kg 仕様/天板:メラミン化粧板 (t28mm) フラッシュ加工 フレ-ム:スチ-ル (〼26mm) メラミン焼付塗装 入数:1 ●スライド脚 ●天板が (RO) (TE) のフレ-ムカラ-はシャンパンゴ-ルド、(IV) のフレ-ムカラ-は シルバ-です。 ● (RO) (TE) の天板は黒、(IV) の天板は白のソフトエッジになります。 ●折畳時:H98mm
RWZ





幼保レンタル・リース
IV:アイボリー TE:チーク RO:ローズ ■天板色 600/ 450 1800/ 1500/ 1200 1540/1290/940 330 275 91 折り畳み時 600/ 450 1800/ 1500/ 1200 1540/1290/940 330 275 91 折り畳み時 1800 1550 337 247 282 600/450 100 折り畳み時 折畳み座卓 棚 天板仕様 価格(税抜)サイズ(mm) 梱包才数梱包重量 RWZ-1860 棚無し ソフトエッジ 62,000円 W1800×D600×H330 4.1才18kg RWZ-1845 53,000円 W1800×D450×H340 3.1才16kg 仕様/天板:メラミン化粧板 (t28mm) ソフトエッジ (ブラック) 脚:スチ-ル メラミン焼付塗装 入数:1 脚間内寸:W1550×D560・脚間内寸:W1550×D430 ●折畳時:H100mm 折畳み座卓 (平板脚) 棚 天板仕様 価格(税抜)サイズ(mm) 梱包才数梱包重量 YKZ-1860H
共張り 39,000円 W1800×D600×H330 4.2才18kg YKZ-1845H 32,000円 W1800×D450×H330 3.2才15kg YKZ-1560H 38,000円 W1500×D600×H330 3.5才15kg YKZ-1545H 31,000円 W1500×D450×H330
棚無し
YKZ-1860 棚無し 共張り 36,000円 W1800×D600×H330 4.2才18kg YKZ-1845 30,000円 W1800×D450×H330 3.2才15kg YKZ-1560 36,000円 W1500×D600×H330
YKZ-1845H(TE)
YKZ-1845HSE(RO)
YKZ-1545(TE)
YKZ-1545SE(RO)
角脚タイプ
平板脚タイプ
RWZ
YKZ YKZ-H
RWZ-1845(TE)
RWZ-1845(RO)
IV:アイボリー TE:チーク RO:ローズ
IV:アイボリー TE:チーク RO:ローズ
227 SOCIA

チェア SFC-2T(BL) P.125
高さ調節脚テーブル
KG

KG-1845T・KG-1860T
昇降機能付折畳み 会議テーブル 棚 天板仕様 価格(税抜)サイズ(mm) 梱包才数梱包重量
KG-1860T 棚付き ソフトエッジ 73,000円 W1800×D600×H700~900 4.2才18kg
KG-1845T
62,000円 W1800×D450×H700~900 3.2才17kg 仕様/天板:メラミン化粧板 (t28mm) フラッシュ加工 ソフトエッジ フレ-ム:スチ-ル (〼28mm) メラミン焼付塗 装 調節部脚:(〼26mm) クロ-ムメッキ 入数:1 ●4段階 (50mmピッチ) で高さ調節が可能です。 ●天 板が (RO) (TE) のフレ-ムカラ-はシャンパンゴ-ルド、(IV) のフレ-ムカラ-はシルバ-です。 ● (RO) (TE) の 天板は黒、(IV) の天板は白のソフトエッジになります。 ●折畳時:H91.5mm
テーブル台車

注意

IV:アイボリー TE:チーク RO:ローズ ■天板色




高さ調節イメージ 4段階(50㎜ピッチ)で 高さ調節が可能です。

黒フレーム仕様も可能です。 ※黒フレーム仕様は別途お 見積りいたします。
お気軽にお問い合わせ下 さい。
昇降機能付折畳み 会議テーブル 棚 天板仕様 価格(税抜)サイズ(mm) 梱包才数梱包重量
KG-1860
棚無し ソフトエッジ 72,000円 W1800×D600×H700~900 4.2才16kg
KG-1845 61,000円 W1800×D450×H700~900 3.2才15kg 仕様/天板:メラミン化粧板 (t28mm) フラッシュ加工 ソフトエッジ フレ-ム:スチ-ル (〼28mm) メラミン焼付塗 装 調節部脚:(〼26mm) クロ-ムメッキ 入数:1 ●4段階 (50mmピッチ) で高さ調節が可能です。 ●天 板が (RO) (TE) のフレ-ムカラ-はシャンパンゴ-ルド、(IV) のフレ-ムカラ-はシルバ-です。 ● (RO) (TE) の 天板は黒、(IV) の天板は白のソフトエッジになります。 ●折畳時:H91.5mm
RN-8は、最大1800×600サイズ積 載時、総高1963mmになります。 収納庫、移動、出入口のサイズの参 考にして下さい。
テーブル台車 (8台用) 価格(税抜)サイズ(mm)梱包才数梱包重量 RN-8 118,000円 W935×D750×H15253.9才 21kg 仕様/フレ-ム:スチ-ル 粉体塗装 (ダ-クグレ-) 入数:1 ●キャスタ-:ストッパ-付2個、ストッパ-無2個
●8台積載可能 (W1200~1800、D450~600mmのテ-ブルに対応)
600/ 450 1800 1695 535 ~ 735 700 ~ 900 92 97 折り畳み時 750 900 450 890 1515 192300300 838 920 827355 380 103
デスク ACS-900 P.139
KG-1845T(TE)
KG-1845T(IV)
KG-1845(TE)
RN-8 RN-8
228

作業台
H740固定タイプ
チェアデスク・収納パーティションテーブルレセプションロビーエクステリアアクセサリー木工


作業台 棚 天板仕様 価格(税抜)サイズ(mm) 梱包才数梱包重量
SUP-1875WWK
SUP-1860WWK

作業台 棚 天板仕様 価格(税抜)サイズ(mm) 梱包才数梱包重量
SUP-1275WWK
SUP-1260WWK
SUP-1245WWK
棚無し ABS
SUP-1845WWK
SUP-1890WWK 棚無し ABS
SUP-1575WWK
SUP-1560WWK
SUP-1545WWK
円 W1500×D750×H740 3.7才28.6kg
仕様/天板:低圧メラミン化粧板 (19㎜厚) メラミン含浸シ-ト (ホワイト) 芯材:パ-ティクルボ-ド ABS樹脂エッ ジ巻 フレ-ム:スチ-ル (20×40mm) 粉体塗装 (シルキ-ホワイト) アジャスタ-付 入数:1(3個口) ●天板 平均分布荷重:150 kg
H950固定タイプ

作業台 棚 天板仕様 価格(税抜)サイズ(mm)
SUPH-1845WWK
SUPH-1575WWK
SUPH-1560WWK
SUPH-1545WWK
SUP-975WWK
SUP-960WWK
SUP-945WWK
66,000円 W1200×D750×H740 3.3才24.1kg
61,000円 W1200×D600×H740 2.8才21kg
58,000円 W1200×D450×H740 2.0才18.6kg
60,000円 W900×D750×H740 2.9才19.8kg
55,000円 W900×D600×H740 2.5才17.3kg
53,000円 W900×D450×H740 1.8才15.3kg
仕様/天板:低圧メラミン化粧板 (19㎜厚) メラミン含浸シ-ト (ホワイト) 芯材:パ-ティクルボ-ド ABS樹脂エッ ジ巻 フレ-ム:スチ-ル (20×40mm) 粉体塗装 (シルキ-ホワイト) アジャスタ-付 入数:1(3個口) ●天板 平均分布荷重:150 kg


作業台 棚 天板仕様 価格(税抜)サイズ(mm) 梱包才数梱包重量
SUPH-1275WWK
SUPH-1260WWK
SUPH-1245WWK
SUPH-975WWK
SUPH-960WWK
SUPH-945WWK
棚無し ABS
円 W1200×D750×H950 3.3才26.3kg
64,000円 W1200×D600×H950 2.8才23kg
61,000円 W1200×D450×H950 2.0才20.4kg
63,000円 W900×D750×H950 2.9才22kg
58,000円 W900×D600×H950 2.5才19.3kg
56,000円 W900×D450×H950 1.8才17.1kg 仕様/天板:低圧メラミン化粧板 (19㎜厚) メラミン含浸シ-ト (ホワイト) 芯材:パ-ティクルボ-ド ABS樹脂エッ ジ巻 フレ-ム:スチ-ル (20×40mm) 粉体塗装 (シルキ-ホワイト) アジャスタ-付 入数:1(3個口) ●天板 平均分布荷重:150 kg
仕様/天板:低圧メラミン化粧板 (19㎜厚) メラミン含浸シ-ト (ホワイト) 芯材:パ-ティクルボ-ド ABS樹脂エッ ジ巻 フレ-ム:スチ-ル (20×40mm) 粉体塗装 (シルキ-ホワイト) アジャスタ-付 入数:1(3個口) ●天板 平均分布荷重:150 kg


天板付きワゴン 棚 天板仕様 価格(税抜)サイズ(mm) 梱包才数梱包重量
HTC-7545WK
HTC-6045WK 61,000円 W600×D450×H740 2.0才11.1kg
棚付き ABS 65,000円 W750×D450×H740 2.3才14kg
HTC-4545WK 60,000円 W450×D450×H740 1.9才10.2kg
仕様/天板:低圧メラミン化粧板(19㎜厚) メラミン含浸シート(ホワイト) 芯材:パーティクルボード ABSエッジ巻き フレーム:スチール 粉体塗装 (シルキーホワイト) キャスター:φ50エラストマー車(ストッパー付き2個・ストッパー無し2 個) 入数:1(3個口) ●棚寸:7545/W600×D400×H40、6045・4545/W400×D400×H40 ●有効内寸: 7545/W544×D344×H278、6045・4545/W344×D344×H278 ●平均分布荷重:50 kg(自重4545WK:9. 7kg/6045WK:10.6kg/7545WK:12.9kg含む)

幼保レンタル・リース
95,000
円 W1800×D900×H740 4.9才37.2kg
83,000
円 W1800×D750×H740 4.1才32.9kg
79,000
円 W1800×D600×H740 3.5才28.6kg
71,000
円 W1800×D450×H740 2.5才25.2kg
79,000
75,000
円 W1500×D600×H740 3.2才24.8kg
67,000
円 W1500×D450×H740 2.3才21.9kg
69,000
梱包才数梱包重量 SUPH-1890WWK 棚無し ABS 100,000円 W1800×D900×H950 6.0才39.8kg SUPH-1875WWK 86,000円 W1800×D750×H950 4.1才35.1kg SUPH-1860WWK 81,000円 W1800×D600×H950 3.5才30.6kg
74,000円 W1800×D450×H950 2.5才27kg
82,000円 W1500×D750×H950 3.7才30.8kg
78,000円 W1500×D600×H950 3.2才26.8kg
69,000円 W1500×D450×H950 2.3才23.7kg
SUP-1875WWK
SUPH-1875WWK
HTC-7545W
HTC-6045W
HTC-4545W
SUPH-1560WWK
SUP-1575WWK
SUPH-1560WWK
229 SOCIA
SUP-960-WWK
ブロー成型テーブル

BT
スタッキング厚 スタッキング用切欠 天板ワイド 脚収納 ストッパー 水抜き穴

従来の折り畳みテーブルと比 べ、薄型化しており省スペー ス収納を可能にしております。


天板の四隅にスタッキング用 の溝が設けてあり、スタッキン グ時にズレにくい仕様になって います。
奥行600mmの幅広天板は 作業スペースをしっかり確保で きます。

脚部が天板部に収納される構 造になっているため、スタッキ ング時はしっかり安定します。




ストッパー付きで脚部をしっかり とホールドします。

天板裏には水抜き穴を備 えており、天板内に浸入し た水を抜くことが可能です。
チェア AFC-2APU(GR) P.124
ブロー成型テーブル 棚天板仕様価格(税抜)サイズ(mm)梱包才数梱包重量 BT-1860B 棚無し ブロー成型 56,000円 W1800×D600×H7002.9才15kg
仕様/天板:樹脂ブロ-成型品 (t54mm) フレ-ム:スチ-ル (〼26mm) メラミン焼付塗装 (ブラック) 入数:1 ●脚間内寸:W1545×D392 ●スタッキング可能 (25台まで)
ブロー成型テーブル 棚天板仕様価格(税抜)サイズ(mm)梱包才数梱包重量 BT-1860S 棚無し ブロー成型 56,000円 W1800×D600×H7002.9才15kg 仕様/天板:樹脂ブロ-成型品 (t54mm) フレ-ム:スチ-ル (〼26mm) メラミン焼付塗装 (シルバ-) 入数:1 ●脚間内寸:W1545×D392 ●スタッキング可能 (25台まで)
スタッキングをする際は、フラットな床面の上で、最大積載25台までとしてください。過積載や不安定な場所での 使用は、破損や歪みなどにつながる可能性がございます。
50mm 600mm 1800 1545 700 655 392 54 50 600 折り畳み時 21 9
注意
BT-1860B
BT-1860S/BT-1860B
スタッキング例
BT-1860S
BT-1860B
230
CBT
チェアデスク・収納パーティションテーブルレセプションロビーエクステリアアクセサリー木工


ブロー成型テーブル (スライド脚)
棚天板仕様価格(税抜)サイズ(mm)梱包才数梱包重量
CBT-1845S 棚無し ブロー成型 42,000円 W1800×D450×H7003.2才15kg
仕様/天板:樹脂ブロ-成型品 (t28mm) フレ-ム:スチ-ル (〼26mm) メラミン焼付塗装(シルバー/ブラック) 入数:1 ●スライド脚 ●スタッキング可能 (天板合わせで25台まで)

ブロー成型座卓
CBT-Z


幼保レンタル・リース
ブロー成型座卓 (スライド脚)
棚天板仕様価格(税抜)サイズ(mm)梱包才数梱包重量
CBT-Z1845S 棚無し ブロー成型 38,000円 W1800×D450×H3303.2才15kg 仕様/天板:樹脂ブロ-成型品 (t28mm) フレーム:スチール (〼26mm) メラミン焼付塗装(ブラック/シルバー) 入数:1 ●スライド脚 ●スタッキング可能 (天板合わせで25台まで)
スタッキングをする際は、フラットな床面の上で、天板合わせの状態で最大25台までとしてください。過積載や不安定な 場所での使用は、破損や歪みなどにつながる可能性がございます。
450 1800 1540 700 176 645 91 折り畳み時 346 393 450 310 310 360 1800 20 アルミプレート 310 310 20 361 16 393 310 361 16 アルミプレートの 部分にテーブルの 貫フレームを組み付ける事ができます。 アルミプレート 天板裏面 91 折り畳み時 450 1800 1540 330 275
注意
CBT-1845S(SV)
CBT-1845S(BK)
CBT-1845S
CB-T-1845
CBT-Z1845S(SV)
CBT-Z1845S(BK)
231 SOCIA
CBT-Z1845S
宴会テーブル

宴会テーブル (円型) 棚天板仕様価格(税抜)サイズ(mm)

注意
※天然木を使用しているため、 天板の色が異なる可能性があります。
仕様/天板:シナベニヤ (t28mm) ソフトエッジ フレ-ム:スチ-ル (〼26mm)


注意
※天然木を使用しているため、 天板の色が異なる可能性があります。
仕様/天板:シナベニヤ (t28mm) ソフトエッジ フレ-ム:スチ-ル (〼26mm) メラミン焼付塗装 入数:1 ●バネ脚 ●折畳時:1800RH、1500RH、1200RHはH900mm、900RHはH120mm

宴会テーブル (長方 形) 棚 天板仕様 価格(税抜)サイズ(mm)
ET-1890
棚無し
ET-0909
仕様/天板:シナベニヤ (t28mm) ソフトエッジ フレ-ム:スチ-ル (〼26mm) メラミン焼付塗装 入数:1 ●バネ脚 ●折畳時:H90mm

注意
※天然木を使用しているため、 天板の色が異なる可能性があります。
梱包才数梱包重量
91,000円 W1800×D900×H700 ▲ 6.1才21kg
88,000円 W1800×D750×H700 5.2才17kg ET-1860 61,000円 W1800×D600×H700 4.2才15kg
51,000円 W1800×D450×H700 3.2才15kg
ソフトエッジ
ET-1875
ET-1845
62,000円 W900×D900×H700 3.4才14kg
梱包才数梱包重量 ET-2000R 棚無し ソフトエッジ 243,000円 φ2000×H700 ▲ 16.6才 ▲ 35kg ET-1800R 163,000円 φ1800×H700 ▲ 13.4才28kg ET-1500R 152,000円 φ1500×H700 ▲ 9.4才24kg ET-1200R 86,000円 φ1200×H700 6.0才23kg ET-900R 67,000円 φ900×H700 3.4才14kg
入数:1
(半円 型) 棚 天板仕様 価格(税抜)サイズ(mm) 梱包才数梱包重量 ET-1800RH
ソフトエッジ 97,000円 W1800×D900×H700 6.1才18kg ET-1500RH 91,000円 W1500×D750×H700 5.2才17kg ET-1200RH 61,000円 W1200×D600×H700 2.8才14kg ET-900RH 58,000円 W900×D450×H700 2.1才12kg
メラミン焼付塗装
●バネ脚 ●折畳時:2000R、1800R、1500R、1200RはH900mm、900RはH120mm 宴会テーブル
棚無し
ET-900R
ET-1200R
ET-1500RH
ET-1800RH
ET-1890
ET-1875
232
チェアデスク・収納パーティションテーブルレセプションロビーエクステリアアクセサリー木工

仕様/天板:シナベニヤ (t28mm) ソフトエッジ フレ-ム:スチ-ル (φ31.8mm) メラミン焼付塗装 (トウホウ色) 入数:1 ●指挟み防止機構付 ●単輪ウレタンキャスタ-仕様 ※天板を真中から折り畳む形状をしたテ-ブルをフライト式テ-ブル、フライトテ-ブルと称しています。

フライト式宴会テーブ ル 棚天板仕様価格(税抜)サイズ(mm)
棚無し ソフトエッジ
仕様/天板:シナベニヤ (t28mm) ソフトエッジ フレ-ム:スチ-ル (φ31.8mm) メラミン焼付塗装 (トウホウ色) 入数:1 ●指挟み防止機構付 ●ナイロンキャスタ-仕様 ※天板を真中から折り畳む形状をしたテ-ブルをフライト式テ-ブル、フライトテ-ブルと称しています。

注意
※天然木を使用しているため、 天板の色が異なる可能性があります。

折畳時 折畳時
注意

指挟み防止機構付 天板が平らになる直前に天板がロックされる指挟 み防止機構付。両手で手前のレバーを矢印の方 向に回してロックを解除し、天板を平らにします。
※天然木を使用しているため、 天板の色が異なる可能性があります。


指挟み防止機構付
天板が平らになる直前に天板がロックされる指挟 み防止機構付。両手で手前のレバーを矢印の方 向に回してロックを解除し、天板を平らにします。

天板裏面
幼保レンタル・リース
ETZ-1800 棚無し ソフトエッジ 250,000円 φ1800×H700 31.0才 ▲ 51kg ETZ-1500 236,000円 φ1500×H700 25.9才 ▲ 43kg ETZ-1200 177,000円 φ1200×H700 20.8才 ▲ 32kg ETZ-900 157,000円 φ900×H700 15.7才 ▲ 31kg
フライト式宴会テーブ ル 棚天板仕様価格(税抜)サイズ(mm)梱包才数梱包重量
梱包才数梱包重量
ETZ-K1890
172,000円 W1800×D900×H700 22.0才 ▲ 39kg ETZ-K1875 161,000円 W1800×D750×H700 18.4才 ▲ 36kg ETZ-K1860 135,000円 W1800×D600×H700 14.8才 ▲ 32kg ETZ-K1845 122,000円 W1800×D450×H700 11.2才 ▲ 31kg
ターンテーブル 天板仕様価格(税抜)サイズ(mm)梱包才数梱包重量 TT-900 ソフトエッジ 76,000円 φ900×H552.7才13kg 仕様/天板:メラミン化粧板 (t21mm) ソフトエッジ 回転板:スチ-ル 入数:1
ETZ-1200
ETZ-K1860 TT-900
233 SOCIA
カフェテーブル



カフェテーブル
ASO-CF750B
ASO-CF750W


ABSエッジ





色々なベースにフィットする定番のカフェテーブルで ソロワーク、複数でミーティングなど使い方は多彩です。
■SOCIAシリーズ天板カラーサンプル





WH:ホワイト NA:ナチュラル MAK:ミディアムオーク BR:ブラウン


天板は5色から、脚フレームはマットブラックとホワイトからお選びいた だけます。


棚天板仕様価格(税抜)サイズ(mm)梱包才数梱包重量
棚無し ABS
64,000円 φ750×H7203.7才11kg
64,000円 φ750×H7203.7才11kg
仕様/天板:抗ウイルスメラミン化粧板 (t20mm) 抗ウイルスABSエッジ(SGRは通常ABS) 天板裏:抗ウイルスバッカ- 芯材:パ-ティクルボ-ド 脚:スチール 粉体塗装(B・ブラック、W・ホワイト) 入数:1(2個口)




カフェテーブル
ASO-CF7575B
棚天板仕様価格(税抜)サイズ(mm)梱包才数梱包重量
棚無し ABS 69,000円 W750×D750×H7203.7才13kg
ASO-CF7575W 69,000円 W750×D750×H7203.7才13kg
仕様/天板:抗ウイルスメラミン化粧板 (t20mm) 抗ウイルスABSエッジ(SGRは通常ABS) 天板裏:抗ウイルスバッカ- 芯材:パ-ティクルボ-ド 脚:スチール 粉体塗装(B・ブラック、W・ホワイト) 入数:1(2個口)
ASO-CF7575B/W
520 720 Φ750 520 720 □750
ASO-WC1(IV)
ASO-CF-750W(NA)
ASO-CF750B(MAK)
ASO-CF7575B(NA)
ABSエッジ
ASO-CF750B(SGR)
ASO-CF7575B(BR)
ASO-CF750W(NA)
ASO-CF7575W(MAK)
ASO-CF750W(BR)
ASO-CF7575W(WH)
ASO-CF750B/W
SGR:ストーングレー
234
ラウンジテーブル
チェアデスク・収納パーティションテーブルレセプションロビーエクステリアアクセサリー木工

チェア
ALES-P-CH-FMS P.113
チェア
ALES-P-CH-FGN P.113
チェア
CFL VCFL
■天板カラーサンプル


IV:アイボリー
WT:ウォールナット

ポイント

耐久性、耐水性に優れたABS樹 脂エッジを採用。

ラウンジテーブル 棚天板仕様価格(税抜)サイズ(mm) 梱包才数梱包重量
CFL-T80
棚無し ABS 72,000円 φ800×H700 3.8才20kg 仕様/天板:メラミン化粧板 (t18mm) ABS樹脂エッジ 芯材:パ-ティクルボ-ド 支柱:スチ-ル (φ60.5mm) 粉体塗装 (シルバ-) ベ-ス:スチ-ル 粉体塗装 (シルバ-) 入数:1(2個口)
ラウンジテーブル 棚天板仕様価格(税抜)サイズ(mm) 梱包才数梱包重量
CFL-T80B
棚無し ABS 75,000円 φ800×H700 3.9才21.9kg
仕様/天板:メラミン化粧板 (t18mm) ABS樹脂エッジ 芯材:パ-ティクルボ-ド 支柱:スチ-ル (φ60.5mm) 粉体塗装 (マットブラック) 入数:1(2個口)
CFH

ハイテーブル
CFH-T60B
棚天板仕様価格(税抜)サイズ(mm) 梱包才数梱包重量
棚無し ABS 73,000円 φ600×H1000 5.9才19.8kg 仕様/天板:メラミン化粧板 (t18mm) ABS樹脂エッジ 芯材:パ-ティクルボ-ド 支柱:スチ-ル (φ60.5mm) 粉体塗装 (マットブラック) 入数:1(2個口)
■カラーサンプル


NA:ナチュラル DBR:ダークブラウン
BR:ブラウン
シルバー塗装

ブラック塗装

ALES-CT(BR) P.118



WH:ホワイト





抗ウイルス ラウンジテーブル 棚天板仕様価格(税抜)サイズ(mm) 梱包才数梱包重量
VCFL-T80S 棚無し ABS 74,000円 φ800×H700 3.9才21.9kg
仕様/天板:抗ウイルスメラミン化粧板 パ-ティクルボ-ド (t18mm) 抗ウイルスABSエッジ 天板裏:抗ウイルス
バッカ- 支柱:スチ-ル (φ60.5mm) 塗装 (シルバ-) ベ-ス:スチ-ル 塗装 (シルバ-) 入数:1(2個口)
抗ウイルス ラウンジテーブル 棚天板仕様価格(税抜)サイズ(mm) 梱包才数梱包重量
VCFL-T80B 棚無し ABS 74,000円 φ800×H700 3.9才21.9kg 仕様/天板:抗ウイルスメラミン化粧板 パ-ティクルボ-ド (t18mm) 抗ウイルスABSエッジ 天板裏:抗ウイルス バッカ- 支柱:スチ-ル (φ60.5mm) 粉体塗装 (マットブラック) ベ-ス:スチ-ル 粉体塗装 (マットブラック) 入数:1(2個口)
VCFH
シルバー塗装

抗ウイルス ハイテーブル
ブラック塗装

幼保レンタル・リース
棚天板仕様価格(税抜)サイズ(mm) 梱包才数梱包重量
VCFH-T60S 棚無し ABS 75,000円 φ600×H1000 5.9才19.8kg
仕様/天板:抗ウイルスメラミン化粧板 パ-ティクルボ-ド (t18mm) 抗ウイルスABSエッジ 天板裏:抗ウイルス バッカ- 支柱:スチ-ル (φ60.5mm) 塗装 (シルバ-) ベ-ス:スチ-ル 粉体塗装 (シルバ-) 入数:1(2 個口)
抗ウイルス ハイテーブル 棚天板仕様価格(税抜)サイズ(mm) 梱包才数梱包重量
VCFH-T60B 棚無し ABS 75,000円 φ600×H1000 5.9才19.8kg
仕様/天板:抗ウイルスメラミン化粧板 パ-ティクルボ-ド (t18mm) 抗ウイルスABSエッジ 天板裏:抗ウイルス
バッカ- 支柱:スチ-ル (φ60.5mm) 粉体塗装 (マットブラック) ベ-ス:スチ-ル 粉体塗装 (マットブラック)
入数:1(2個口)
CFL-T60B(BR)
CFL-T80B(WT)
CFL-T80(IV)
CFH-T60B(WT)
VCFL-T80S(WH)
VCFL-T80B(NA)
235 SOCIA
VCFH-T60S(DBR) VCFH-T60B(NA)
プランターテーブル









オフィスグリーンを備え付けることにより 創造性や癒し効果を演出する プランターテーブル
■SOCIAシリーズ天板カラーサンプル

BR:ブラウン



WH:ホワイト NA:ナチュラル MAK:ミディアムオーク


SGR:ストーングレー

ASO配線ホール

プランター内寸:860X220XD5・150・180
プランターテーブル 棚天板仕様価格(税抜)サイズ(mm)梱包才数梱包重量 ASO-PT1790 棚付き ABS 214,000円 W1760×D900×H9005.9才53kg
仕様/天板:パ-ティクルボ-ド 抗ウイルスメラミン化粧板 (t22mm) 抗ウイルスABSエッジ(SGRは通常ABS)
天板裏:抗ウイルスバッカ- 本体:パ-ティクルボ-ド 抗ウイルスメラミン化粧板 脚:スチ-ル 粉体塗装 (マットブラック) 入数:1(4個口) ●天板:W1500×D900 ●天板高:H720 ●配線ホ-ル付

プランター内寸:1160X220XD5・150・180
プランター 片面ハイテーブル 棚天板仕様価格(税抜)サイズ(mm)梱包才数梱包重量 ASO-PT1271KH 棚付き ABS 239,000円 W1200×D710×H11005.0才56kg 仕様/天板:パ-ティクルボ-ド 抗ウイルスメラミン化粧板 (t22mm) 抗ウイルスABSエッジ(SGRは通常ABS) 天板裏:抗ウイルスバッカ- 本体:パ-ティクルボ-ド 抗ウイルスメラミン化粧板 脚:スチ-ル 粉体塗装 (マットブラック) 入数:1(4個口) ●天板:W1200×D450 ●天板高:H1000 ●配線ホ-ル付 ●可動棚1枚付

プランター内寸:1160X220XD5・150・180
抗ウイルスメラミン化粧板 脚:スチ-ル 粉体塗装 (マットブラック) 入数:1(4個口) ●天板(片側):W1200×D450 ●天板高:H1000 ●配線ホ-ル付 ●可動棚1枚付
260 1160 330 909 450 1160 320 1200 838 1100 1000 プランター内寸: 260 1160 330 909 450 710 320 1200 838 1100 1000 プランター内寸: 1160X220XD5・150・180 プランター内寸: 260 860 200 700 1500 1760 150 900 558 900 720 658 1400 プランター 両面ハイテーブル 棚天板仕様価格(税抜)サイズ(mm)梱包才数梱包重量 ASO-PT1211RH 棚付き ABS 267,000円 W1200×D1160×H1100 5.3才69kg 仕様/天板:パ-ティクルボ-ド 抗ウイルスメラミン化粧板 (t22mm) 抗ウイルスABSエッジ(SGRは通常ABS) 天板裏:抗ウイルスバッカ- 本体:パ-ティクルボ-ド
ASO-PT1790(MAK)
ASO-PT1271KH(BR)
ASO-PT1271KH(NA)
ASO-PT1790(WH)
ASO-PT1211RH(NA)
ASO-PT1211RH(BR)
ASO-PT1790
ASO-PT1271KH
ASO-PT1211RH
ASO-PT1271KH(BR)
236
ALES-CTB(BR)
カウンターテーブル
チェアデスク・収納パーティションテーブルレセプションロビーエクステリアアクセサリー木工







■SOCIAシリーズ天板カラーサンプル




WH:ホワイト NA:ナチュラル MAK:ミディアムオーク BR:ブラウン

SGR:ストーングレー

カウンターテーブル 棚 天板仕様 価格(税抜)サイズ(mm) 梱包才数梱包重量
ASO-CT1845B 棚無し ABS
ASO-CT1845W
82,000円 W1800×D450×H720 5.3才35.8kg
82,000円 W1800×D450×H720 5.3才35.8kg 仕様/天板:抗ウイルスメラミン化粧板 (t22mm) 抗ウイルスABSエッジ(SGRは通常ABS) 天板裏:抗ウイルス バッカ- 脚:スチ-ル 粉体塗装 (B・ブラック、W・ホワイト) 入数:1(3個口)
ハイカウンターテーブル

カウンターテーブル (幕 板付) 棚 天板仕様 価格(税抜)サイズ(mm) 梱包才数梱包重量
ASO-CT1845MB 棚無し ABS 115,000円 W1800×D450×H720 6.5才40.8kg
ASO-CT1845MW 115,000円 W1800×D450×H720 6.5才40.8kg
仕様/天板:抗ウイルスメラミン化粧板 (t22mm) 抗ウイルスABSエッジ(SGRは通常ABS) 天板裏:抗ウイルス バッカ- 脚:スチ-ル 粉体塗装 (B・ブラック、W・ホワイト) 入数:1(4個口)




カウンターテーブル 棚 天板仕様 価格(税抜)サイズ(mm) 梱包才数梱包重量
ASO-HCT1845B 棚無し ABS 89,000円 W1800×D450×H1000 6.7才38.2kg
ASO-HCT1845W 89,000円 W1800×D450×H1000 6.7才38.2kg
仕様/天板:抗ウイルスメラミン化粧板 (t22mm) 抗ウイルスABSエッジ(SGRは通常ABS) 天板裏:抗ウイルス バッカ- 脚:スチ-ル 粉体塗装 (B・ブラック、W・ホワイト) 入数:1(3個口)





幼保レンタル・リース
カウンターテーブル (幕板付) 棚 天板仕様 価格(税抜)サイズ(mm) 梱包才数梱包重量
ASO-HCT1845MB 棚無し ABS 119,000円 W1800×D450×H1000 8.9才43.2kg
ASO-HCT1845MW 119,000円 W1800×D450×H1000 8.9才43.2kg 仕様/天板:抗ウイルスメラミン化粧板 (t22mm) 抗ウイルスABSエッジ(SGRは通常ABS) 天板裏:抗ウイルス バッカ- 脚:スチ-ル 粉体塗装 (B・ブラック、W・ホワイト) 入数:1(4個口)
中野 2020.11.12 訂正 中野 2022.3.23 X 0.015 縮尺 638 440 450 1800 1670 720 中野 2020.11.12 訂正 中野 2022.3.23 X 0.015 縮尺 918 440 450 1800 1670 1000 638 398 440 450 1800 1670 720 918 440 450 1800 1670 1000 678
ASO-S9045B (MAK)
ASO-HCT1845B(NA)
ASO-WC2F-NA(MS)
ASO-CT1845B(NA)
ASO-CT1845W(WH)
ASO-CT1845MW(BR)
ASO-CTB(LGN)
ASO-CTB(BL)
ASO-HCT1845B(BR)
ASO-HCT1845W(MAK)
ASO-HCT1845MB(SGR)
ASO-CT1845B/W ASO-HCT1845B/W
ASO-CT1845MB/MW
237 SOCIA
ASO-HCT1845MB/MW
テーブル

ASO-T









■天板カラーサンプル

BR:ブラウン


WH:ホワイト NA:ナチュラル MAK:ミディアムオーク


SGR:ストーングレー


テーブル 棚天板仕様価格(税抜) サイズ(mm)梱包才数梱包重量
ASO-T1890B
ASO-T1575B
棚無し ABS 99,000円 W1800×D900×H7207.3才 ▲ 31.2kg
91,000円 W1500×D750×H7205.6才26.5kg
仕様/天板:抗ウイルスメラミン化粧板(22mm厚)フラッシュ加工 抗ウイルスABSエッジ(SGRは通常ABS) 天板裏:抗ウイルスバッ カー 脚:スチール 粉体塗装(ブラック) 入数:1(2個口)
1800/1500 1638/1338 900/750 700 1764/1464 720 625
ASO-T1575B(SGR)
KRM−430G(BL)
ASO-T1575B(BR)
ASO-T1575B(MAK)
ASO-T1575B(SGR)
ASO-T1575B(WH)
238
抗ウイルス 食堂用テーブル
チェアデスク・収納パーティションテーブルレセプションロビーエクステリアアクセサリー木工


SIK-V ALES用フック付


抗ウイルス食堂用
テーブル (椅子掛け付) 棚 天板仕様 価格(税抜)サイズ(mm) 梱包才数梱包重量
SIK-1875VA 棚無し ABS 210,000円 W1800×D750×H700
▲ 4.5才31.3kg 仕様/天板:抗ウイルスメラミン化粧板 (t28mm) 抗ウイルスABSエッジ 脚:スチ-ル メラミン焼付塗装 金具:スチ-ル メラミン焼付塗装 入数:1(4個口) ●対応機種:ALES全般 (ALES-CT、ALES-CTBは対象外)
MK-480用フック付


抗ウイルス食堂用
テーブル (椅子掛け付) 棚 天板仕様 価格(税抜)サイズ(mm) 梱包才数梱包重量
SIK-1875VM 棚無し ABS 210,000円 W1800×D750×H700 ▲ 4.4才30.8kg 仕様/天板:抗ウイルスメラミン化粧板 (t28mm) 抗ウイルスABSエッジ 脚:スチ-ル メラミン焼付塗装 金具:スチ-ル メラミン焼付塗装 入数:1(4個口) ●対応機種:MK-480、SFIDA、SFIDA-B、SFIDA-C1








WH:ホワイト NA:ナチュラル BR:ブラウン








WH:ホワイト NA:ナチュラル BR:ブラウン





 チェア ALES-T-NA P.116
SIK-1875VA(NA)
SIK-1875VM(NA)
MK-480(WH)
SIK-1875VA(NA)
SIK-1875VA(BR)
SIK-1875VM(NA)
SIK-1875VM(WH)
ALES用フック
MK用フック
ALES設置
MK-480設置
対応チェア
ALES-CH-B ALES-H-BR ALES-T-NA-B
チェア ALES-T-NA P.116
SIK-1875VA(NA)
SIK-1875VM(NA)
MK-480(WH)
SIK-1875VA(NA)
SIK-1875VA(BR)
SIK-1875VM(NA)
SIK-1875VM(WH)
ALES用フック
MK用フック
ALES設置
MK-480設置
対応チェア
ALES-CH-B ALES-H-BR ALES-T-NA-B
■天板カラーサンプル
■天板カラーサンプル
MK-480 SFIDA SFIDA-B SFIDA-C1 239 SOCIA
対応チェア
幼保レンタル・リース
ラウンジテーブル








ラウンジソファやベンチで使いやすいサイズです。
棚板付きタイプは、作業スペースを広くします。
■SOCIAシリーズ天板カラーサンプル





SGR:ストーングレー WH:ホワイト NA:ナチュラル MAK:ミディアムオーク BR:ブラウン



カフェテーブル 棚 天板仕様 価格(税抜)サイズ(mm) 梱包才数梱包重量
ASO-CF1260B 棚無し ABS 65,000円 W1200×D600×H6505.4才24.9kg
ASO-CF1260W 65,000円 W1200×D600×H6505.4才24.9kg 仕様/天板:抗ウイルスメラミン化粧板 (t22mm) フラッシュ加工 抗ウイルスABSエッジ(SGR は通常ABS) 天板裏:抗ウイルスバッカ- 脚:スチール 粉体塗装(B・ブラック、W・ホワイト) 入数:1(2個口)




カフェテーブル 棚 天板仕様 価格(税抜)サイズ(mm) 梱包才数梱包重量
ASO-CF6060B 棚無し ABS 50,000円 W600×D600×H6502.9才17kg
ASO-CF6060W 50,000円 W600×D600×H6502.9才17kg
仕様/天板:抗ウイルスメラミン化粧板 (t22mm) フラッシュ加工 抗ウイルスABSエッジ(SGR は通常ABS) 天板裏:抗ウイルスバッカ- 脚:スチール 粉体塗装(B・ブラック、W・ホワイト) 入数:1(2個口)



カフェテーブル 棚 天板仕様 価格(税抜)サイズ(mm) 梱包才数梱包重量
ASO-CF1040B 棚付き ABS 87,000円 W1000×D400×H6504.0才25kg
ASO-CF1040W 87,000円 W1000×D400×H6504.0才25kg
仕様/天板:抗ウイルスメラミン化粧板 (t22mm) フラッシュ加工 抗ウイルスABSエッジ(SGR は通常ABS) 天板裏:抗ウイルスバッカ- 脚:スチール 粉体塗装(B・ブラック、W・ホワイト) 入数:1(3個口)
41 5 400 1000 650 15 1 326 328 928 596 528 600 1200 1128 650 596 528 600 600 528 650
ASO-CF1260B(SGR)
ASO-CF1260W(BR)
ASO-CF1260W(NA)
ASO-CF1260
ASO-CF1040
ASO-CF1040B(BR)
ASO-CF1040W(MAK)
ASO-CF1040W(WH)
ASO-CF6060
ASO-CF6060B(MAK)
ASO-CF6060B(NA)
ASO-CF6060W(BR)
ASO-CF6060W(SGR)
240
テーブル&デスク
チェアデスク・収納パーティションテーブルレセプションロビーエクステリアアクセサリー木工






■SOCIAシリーズ天板カラーサンプル





SGR:ストーングレー
ASO-WT
ASO-WT6045B(BR)


ASO-WT6045B(WH)

棚天板仕様価格(税抜) サイズ(mm) 梱包才数梱包重量
仕様/天板:抗ウイルスメラミン化粧板 (t22mm) 抗ウイルスABSエッジ(SGRは通常ABS) 天板裏:抗ウイルスバッカ- 脚:スチ-ル 粉体塗装 (ブラック) 入数:1(2個口)

ASO-ST

ASO-ST400B(NA)

ASO-ST400B(WH)

ASO-WT6045B(MAK)
サイドテーブル 棚天板仕様価格(税抜)サイズ(mm)梱包才数梱包重量
ASO-ST400B
ASO-ST4540B
69,000円 φ440×H7202.2才15.4kg
71,000円 W450×D440×H7202.2才16.1kg
仕様/天板:抗ウイルスメラミン化粧板 (t22mm) 抗ウイルスABSエッジ(SGRは通常ABS) 天板裏:抗ウイルスバッカ- 脚:スチ-ル 粉体塗装 (ブラック) 入数:1(2個口)

ASO-WD

ASO-WD6050B(NA)
ASO-WT6045B

ASO-ST4540B(SGR)
ASO-ST400B

ASO-WD6050B(SGR)

ASO-ST4540B(MAK)
ASO-ST4540B

幼保レンタル・リース
720 Φ400 Φ440 720 450 400 Φ440 500 720 518 600 698 548 400 450 720 600 ワークデスク 棚天板仕様価格(税抜)サイズ(mm)梱包才数梱包重量 ASO-WD6050B 棚無し ABS 72,000円 W600×D500×H7205.2才16.1kg 仕様/天板:抗ウイルスメラミン化粧板 (t22mm) 抗ウイルスABSエッジ(SGRは通常ABS) 天板裏:抗ウイルスバッカ- 本体:抗ウイルスメラミ ン化粧板 脚:スチ-ル 粉体塗装 (ブラック) 入数:1(2個口)
ASO-WT6045B
60,000円
ワークテーブル
棚無し ABS
W600×D450×H720 2.2才 15.7kg
棚無し ABS
内側
ASO-WT6045B(NA)
WH:ホワイト NA:ナチュラル MAK:ミディアムオーク BR:ブラウン
ASO-OC1(GR)
ASO-SP1B(GR)
241 SOCIA
ASO-OC1(GR)

NZH
落ち着いた色合いの木肘が全体の重厚感を高めます。





750 380 600 135 490 680 590 830 750 380 600 135 490 680 1290 1530 750 380 600 135 1640 1880 490 680 応接ソファ 価格(税抜) サイズ(mm) 梱包才数梱包重量 NZH-1 119,000円 W830×D680×H750 (SH380)18.2才20kg NZH-2 167,000円 W1530×D680×H750 (SH380) ▲ 34.0才 ▲ 30kg NZH-3 193,000円 W1880×D680×H750 (SH380) ▲ 41.0才 ▲ 34kg 仕様/本体:木枠 合成皮革 (PUレザ-) 木肘:MDF (表面突板貼り) ウレタン塗装 入数:1
応接ソファ
NZH-1(BK) KVT-1260(WN)
NZH-3(BK)
NZH-1(BK)
NZH-2(BK)
NZH-1 NZH-2 NZH-3 木肘 汚れやすいアームには木肘を使用し、メンテナンス性にも配慮 しています。 BK:ブラック ■カラーサンプル 242
ロビー Lobby エクステリア Exterior アクセサリー Accessories Woodworking 福祉 Welfare Kindergarten レンタル・リース Rental / Lease
NZH-3(BK)
Reception
チェアデスク・収納パーティションテーブルレセプションロビーエクステリアアクセサリー木工

NZ-A
抗菌・耐アルコール・耐次亜塩素酸の機能が付いた張地を使用した 高級感のある応接ソファ。



応接ソファ 価格(税抜) サイズ(mm) 梱包才数梱包重量
NZ-A1 135,000円 W830×D680×H750 (SH380)15.0才25kg
NZ-A2
NZ-A3
円 W1530×D680×H750 (SH380)
円 W1880×D680×H750 (SH380)
仕様/本体:木枠 合成皮革 (PVC) 脚:スチ-ル (φ38mm) クロ-ムメッキ
幼保レンタル・リース



750 490 680 590 830 380 600 135 750 380 600 135 1290 1530 490 680 750 380 600 135 1640 1880 490 680
▲ 27.9才 ▲ 37kg
192,000
▲ 34.1才 ▲
224,000
48kg
入数:1
NZ-A3(BK)
BK:ブラック GN:グリーン BL:ブルー ■カラーサンプル
NZ-A3
NZ-A1 NZ-A2
NZ-A1(GN)
NZ-A2(BL)
NZ-A1(GN)
OT-1260(WT)
243 SOCIA
NZ-A1(GN)
応接ソファ

NZ
シンプルながら存在感のあるデザインで、重厚感ある空間を演出します。



応接ソファ 価格(税抜) サイズ(mm) 梱包才数梱包重量
NZ-1 112,000円 W830×D680×H750 (SH380)15.0才25kg

750 490 680 590 830 380 600 135 750 380 600 135 1290 1530 490 680 750 380 600 135 1640 1880 490 680
W1530×D680×H750
▲ 27.9才 ▲ 37kg
NZ-2 158,000円
(SH380)
▲ 34.1才 ▲ 48kg 仕様/本体:木枠
クロ-ムメッキ 入数:1
NZ-3 187,000円 W1880×D680×H750 (SH380)
合成皮革 (PUレザ-) 脚:スチ-ル (φ38mm)
SOCIA G-GL P.071
NZ-1(BK)
NZ-3(BK)
KVT-1260(WN)
NZ-1(BK)
NZ-1 NZ-2
NZ-3
NZ-2(BK)
BK:ブラック ■カラーサンプル 244
NZ-3(BK)
ラウンジチェア
チェアデスク・収納パーティションテーブルレセプションロビーエクステリアアクセサリー木工

LKC
様々なシーンに使用できるラウンジチェア。
背と座にはアクセントとしてダブルステッチで縫製されています。




■カラーサンプル




デザインのアクセントとして、ブラック色のダブルステッチで縫製 しています。
ラウンジチェア 価格(税抜) サイズ(mm)梱包才数梱包重量
LKC-580 117,500円 W580×D690×H720(SH400)12.5才12kg
幼保レンタル・リース
仕様/背・座:キャンパスクッション布張り 脚:スチール(Φ22.2mm) 粉体塗装(ダークグレー) 入数:1 ●ダブルステッチ付
720 400 635 580 690 465 535
LKC-580(BR)
LKC-580(IV)
LKC-580(LGR) 背面仕様
ダブルステッチ縫製
LGR:ライトグレー
BR:ブラウン IV:アイボリー
LKC-580
ASO-OT1200(MAK)
LKC-580(IV)
245 SOCIA
ASO-BLS(IV)

KOT
応接シーンだけでなくエントランスの 待合いスペースにも最適。





応接イス 価格(税抜) サイズ(mm) 梱包才数梱包重量
KOT-1080 150,000円 W1080×D630×H750 (SH410) ▲ 24.1才23kg
KOT-580 107,000円 W580×D630×H750 (SH410)12.7才14.3kg 仕様/背・座:合板 合成皮革 (PVC) 脚:スチ-ル (20×30mm) クロ-ムメッキ 肘:MDF


750 632 455 580 500 550 41 0 750 632 455 1080 1000 550 41 0
(表面突板貼り) ウレタン塗装 入数:1
KOT-580(BK)
OT-1260(WT)
KOT-1080(BK)
KOT-580(BK)
KOT-580(CGR)
KOT-1080(BK)
KOT-1080(CGR)
KOT-580
KOT-1080
BK:ブラック
CGR:チャコールグレー ■カラーサンプル
KOT-580(CGR)
246
OT-4560(WT)
チェアデスク・収納パーティションテーブルレセプションロビーエクステリアアクセサリー木工

ZCL
ZC 会議や打合せにも最適な応接チェア。


キャスターチェア 価格(税抜) サイズ(mm) 梱包才数梱包重量
ZCL-590 98,000円 W590×D610×H790 (SH440)11.7才 16kg 仕様/本体:木枠 合成皮革 (PUレザ-) 入数:1 ●キャスタ-付:ストッパ-無4個
PU 布


キャスターチェア 価格(税抜) サイズ(mm) 梱包才数梱包重量
ZC-590 92,000円 W590×D610×H790 (SH440)11.7才 16kg 仕様/本体:木枠 布張り 入数:1 ●キャスタ-付:ストッパ-無4個


BR:ブラウン BK:ブラック


IV:アイボリー
幼保レンタル・リース


460 610 440 61 0 590 470 790
テーブル NOTK-2412(WT) P.207
ZC-590(DGR)
ZC-590(BJ)
ZC-590(DGR)
ZCL-590(BR)
ZCL-590(BK)
ZC/ZCL
■カラーサンプル DGR:ダークグレー BJ:ベージュ ■カラーサンプル
247 SOCIA
ZCL-590(IV)
応接テーブル

ASO-OT1260(MAK)
ASO-OT
■カラーサンプル








抗ウイルスセンター テーブル 価格(税抜) サイズ(mm)
梱包才数梱包重量
ASO-OT1260 130,000円 W1200×D600×H4202.8才22kg
仕様/天板:抗ウイルスメラミン化粧板(30㎜厚) 共張り 天板裏:抗ウイルスバッカー 側板:抗ウイルスメラミン化粧板 入数:1 ●アジャスター付

KVTシリーズ
天板下に雑誌などが置ける 棚板付きのセンターテーブル。

センターテーブル 価格(税抜) サイズ(mm) 梱包才数梱包重量
KVT-1260 46,000円 W1200×D600×H420 5.4才 21kg
仕様/天板:フラッシュ加工 (t26.6mm) タモ突板貼り(PU塗装) 棚板:MDF (t18mm) タモ突板貼り(PU塗装) 脚:天然木 (ラバ-ウッド) 塗装 入数:1
※直接熱い湯呑などを置くと白く跡がつきます。必ず、コースターなどを敷いて熱が直接伝わらないようにご使用下さい。 ※ビニールや樹脂製品の種類によっては、天板、棚板等の表面塗料と化学反応を起こして軟化やベトツキを生じることがありますのでご注意下さい。
420 1200 1118 380 600 1200 1034 420 1891 20 600 434 423
KVT-1260(WN)
ASO-OT1260(MAK)
ASO-OT1260(BR)
ASO-OT1260(NA)
KVT-1260
ASO-OT1260
SGR:ストーングレー
WH:ホワイト NA:ナチュラル MAK:ミディアムオーク
BR:ブラウン
LKC-580(IV)
248
ASO-BLS(IV)
応接テーブル
OTシリーズ 応接ソファに合わせやすいセンター・サイドテーブル。
チェアデスク・収納パーティションテーブルレセプションロビーエクステリアアクセサリー木工




センターテーブル 価格(税抜)サイズ(mm)梱包才数梱包重量
OT-1260 61,000円 W1200×D600×H4503.4才 12kg
仕様/天板:メラミン化粧板 (t21mm) 脚:スチ-ル (20×30mm) クロ-ムメッキ 貫:スチ-ル (20×30mm) クロ-ムメッキ 入数:1


サイドテーブル 価格(税抜)サイズ(mm)梱包才数梱包重量
OT-4560 49,800円 W450×D600×H5001.5才 7kg
仕様/天板:メラミン化粧板 (t21mm) 脚:スチ-ル (20×30mm) クロ-ムメッキ 貫:スチ-ル (20×30mm) クロ-ムメッキ 入数:1
山中シリーズ 高級感のあるクロームメッキ脚と、落ち着いたアイボリー色天板の センターテーブルとサイドテーブル。

センターテーブル 価格(税抜)サイズ(mm)梱包才数梱包重量 山中センターテーブル 54,000円 W1100×D600×H420 4.7才13kg 仕様/天板:メラミン化粧板 (t27mm) (アイボリ-) 脚:スチ-ル (φ31.8mm) クロ-ムメッキ 入数:1

サイドテーブル 価格(税抜)サイズ(mm)梱包才数梱包重量 山中サイドテーブル 38,900円 W550×D550×H4202.0才11kg 仕様/天板:メラミン化粧板 (t27mm) (アイボリ-) 脚:スチ-ル (φ31.8mm) クロ-ムメッキ 入数:1
TAシリーズ シックな黒塗装フレームのセンターテーブル。


幼保レンタル・リース
センターテーブル 価格(税抜)サイズ(mm)梱包才数梱包重量
TA-1260B 49,200円 W1200×D600×H4503.3才 13.1kg
仕様/天板:メラミン化粧板 (t21mm) フラッシュ加工 ABSエッジ 脚:スチ-ル メラミン焼付塗装 (ブラック) 入数:1
●脚間内寸:W1140×D560
1200 1015 450 399 600 405 450 449 500 600 560 450 600 1200 1140 339 550 465 420 340 550 465 530 600 1100 1015 420 340 465 530
OT-1260(IV)
OT-1260(WT)
OT-4560(IV)
OT-4560(WT)
OT-1260
OT-4560
山中センターテーブル
山中サイドテーブル
山中センターテーブル
山中サイドテーブル
TA-1260B(WH)
TA-1260B(WT)
TA-1260B
OT-1260(WT)
NZ-A1(GN)
KOT-580(CGR)
249 SOCIA
OT-4560(WT)









ラウンジベンチ 価格(税抜) サイズ(mm) 梱包才数梱包重量
ASO-L01B 61,000円 W500×D500×H4301.8才 8.5kg
ASO-L01W 61,000円 W500×D500×H4301.8才 8.5kg
仕様/座:合板 スラブウレタン+チップウレタン 布張り (ポリエステル100%) 脚:スチ-ル (〼31mm) スチール 粉体塗装(B・ブラック、 W・ホワイト) 入数:1
1人掛+テーブル








ラウンジベンチ (天板付) 価格(税抜) サイズ(mm) 梱包才数梱包重量
ASO-L02TB 89,000円 W1000×D500×H4303.5才 15kg
ASO-L02TW 89,000円 W1000×D500×H4303.5才 15kg 仕様/座:合板 スラブウレタン+チップウレタン 布張り (ポリエステル100%) 天板:抗ウイルスメラミン 抗ウイルスABSエッジ 天板裏:抗ウイルスバッカ- 脚:スチ-ル(〼31mm) スチール 粉体塗装(B・ブラック、W・ホワイト) 入数:1 ●天板高:352mm

430 418 500 290 398 500 352 918 398 500 500 290 500 1000 430
ラウンジベンチ
ASO-L01B(LGN)
ASO-L02TB(BR)
ちょっと休憩に最適なコンパクトベンチ。
G-TP2+G-TP1
ASO-L 1人掛
PK : ピンク LGN : ライトグリーン BR : ブラウン BL : ブルー ■カラーサンプル ※製法の特性上、繊維の流れる方向により、色が異なって見えることがあります。
ASO-L02T
ASO-L01
ASO-L02TB(BR)
ASO-L01B(BL)
ASO-L01B(PK)
ASO-L01W(BR)
ASO-L01W(LGN)
■天板 NA : ナチュラル 250 Lobby Exterior アクセサリー Accessories Woodworking Welfare Kindergarten レンタル・リース Rental / Lease
ASO-L02TW(PK)
くつろぎのひと時やライトワークにも応えます。
2人掛
チェアデスク・収納パーティションテーブルレセプションロビーエクステリアアクセサリー木工

ASO-L02B(LGN)
ASO-L02W(BL)

ラウンジベンチ 価格(税抜) サイズ(mm) 梱包才数梱包重量
ASO-L02B 89,000円 W1000×D500×H4303.5才 14kg
ASO-L02W 89,000円 W1000×D500×H4303.5才 14kg
仕様/座:合板 スラブウレタン+チップウレタン 布張り (ポリエステル100%) 脚:スチ-ル (〼31mm) スチール 粉体塗装(B・ブラック、 W・ホワイト) 入数:1
3人掛

ASO-L03B(BR)

ASO-L03B(PK)
ASO-L02

ASO-L03W(BL)

ラウンジベンチ 価格(税抜) サイズ(mm) 梱包才数梱包重量 ASO-L03B
ASO-L03W 120,000円 W1500×D500×H4305.3才 18kg
仕様/座:合板 スラブウレタン+チップウレタン 布張り (ポリエステル100%) 脚:スチ-ル (〼31mm) スチール 粉体塗装(B・ブラック、 W・ホワイト) 入数:1
ラウンジサイドテーブル






ASO-L03W(LGN)
ASO-L03



ASO-LT8050(MAK)
幼保レンタル・リース
ASO-LT8050(WH)

234 500 430 756 800 234 288 258 1 28 494 450 430 918 500 290 500 1000 398 500 430 1418 398 500 500 290 500 1500 500 ラウンジサイドテーブル 価格(税抜) サイズ(mm) 梱包才数梱包重量 ASO-LT8050 120,800円 W800×D500×H4301.3才 19.6kg 仕様/天板:抗ウイルスメラミン化粧板 (t22mm) 天板裏:抗ウイルスパッカ- 本体:抗ウイルスメラミン化粧板 入数:1
120,000円 W1500×D500×H4305.3才 18kg
ASO-LT8050(BR)
ASO-LT8050(NA)
SGR:ストーングレー MAK:ミディアムオーク WH:ホワイト
BR:ブラウン NA:ナチュラル
251 SOCIA
■カラーサンプル
ベンチシステム



ASO-SB





■カラーサンプル

BR:ブラウン

システムベンチ 価格(税抜) サイズ(mm)梱包才数梱包重量
ASO-SB1200R 132,000円 W1200×D565×H3803.2才25kg 仕様/天板:パーティクルボード 抗ウイルスメラミン化粧板(t30mm)ABSエッジ 抗ウイルスABSエッジ(SGRは 通常ABS) 本体:メラミン化粧板 入数:1


WH:ホワイト NA:ナチュラル MAK:ミディアムオーク



システムベンチ 価格(税抜) サイズ(mm)梱包才数梱包重量 ASO-SB900S 99,000円 W900×D450×H3801.9才22kg 仕様/天板:パーティクルボード 抗ウイルスメラミン化粧板(t30mm)ABSエッジ 抗ウイルスABSエッジ(SGRは 通常ABS) 本体:メラミン化粧板 入数:1
450 900 840 380 380 350 227127 850 850 450 1200
380 350
R850
ASO-SB1200R
ASO-SB900S
SGR:ストーングレー
ASO-ST400R(SGR)
ASO-SB1200R(MAK)
ASO-SB1200R(MAK)
ASO-SB900S(MAK)
ASO-PB1530H(NA)
ASO-ST400R(NA)
CK03(GN)
ASO-W1111W(WH)
ASO-SB1200R(MAK)
ASO-SB900S(MAK)
252
ASO-SB1200R(BR)

チェアデスク・収納パーティションテーブルレセプションロビーエクステリアアクセサリー木工

ASO-BLS オフィス、カフェ、ラウンジなど様々なシーンで使用できる収納ボックスソファ。 使用環境に応じた備品等を保管できます。


ASO-BLS(LGR)


収納付き
片側内寸:W700×D490×H189 ㎜ 使用環境に応じた備品や生活必需品の保管、 防災関連グッズ等の収納に重宝します。

収納ボックスソファ 価格(税抜) サイズ(mm) 梱包才数梱包重量
ダブルステッチ縫製 デザインのアクセントとして、 ブラック色のダブルステッチ で縫製しています。
■カラーサンプル

BR:ブラウン

LGR:ライトグレー
■台輪
幼保レンタル・リース

SGR:ストーングレー
ASO-BLS 260,000円 W1500×D600×H730(SH400)26才 48kg 仕様/背・座:チップウレタン布張り(アクリル40%、ポリエステル30%、綿30%) 台輪:抗ウイルスメラミン化粧板 入数:1(3個口) ●収納機能付 ●収納内寸:W700×D490×H189㎜×2 ●ダブルステッチ仕様 ●アジャスター付 ASO-BLS

IV:アイボリー
730 1500 400 250 150 1480 700 490 189 540 600 400 315
ボックスソファ
ASO-OT1260(MAK)
ASO-PB1530L(NA)
ASO-BLS(IV)
ASO-BLS(BR)
253 SOCIA






ASO-CF6060W(NA)








SGR:ストーングレー


ASO-CF6060W(WH)
カフェテーブル 価格(税抜)サイズ(mm)梱包才数梱包重量
ASO-CF6060B 50,000円 W600×D600×H6502.9才17kg
ASO-CF6060W 50,000円 W600×D600×H6502.9才17kg
仕様/天板:抗ウイルスメラミン化粧板 (t22mm) フラッシュ加工 抗ウイルスABSエッジ(SGRは通常ABS) 天板裏:抗ウイルスバッカ- 脚:スチール 粉体塗装(B・ブラック、W・ホワイト) 入数:1(2個口)

ASO-CF1040W(BR)

ASO-CF1040W(MAK)

ASO-CF6060B(SGR)
ASO-CF1040B(NA)

カフェテーブル 価格(税抜)サイズ(mm)梱包才数梱包重量
ASO-CF1040B 87,000円 W1000×D400×H6504.0才25kg
ASO-CF1040W 87,000円 W1000×D400×H6504.0才25kg 仕様/天板:抗ウイルスメラミン化粧板 (t22mm) フラッシュ加工 抗ウイルスABSエッジ(SGRは通常ABS) 天板裏:抗ウイルスバッカ- 脚:スチール 粉体塗装(B・ブラック、W・ホワイト) 入数:1(3個口)

ASO-CF1260W(SGR)


ASO-CF1260B(MAK)

カフェテーブル 価格(税抜)サイズ(mm)梱包才数梱包重量
ASO-CF1260B 65,000円 W1200×D600×H6505.4才24.9kg
ASO-CF1260W 65,000円 W1200×D600×H6505.4才24.9kg 仕様/天板:抗ウイルスメラミン化粧板 (t22mm) フラッシュ加工 抗ウイルスABSエッジ(SGRは通常ABS) 天板裏:抗ウイルスバッカ- 脚:スチール 粉体塗装(B・ブラック、W・ホワイト) 入数:1(2個口)



ASO-LT8050(WH)

41 5 400 1000 650 15 1 326 328 928 596 528 600 1200 1128 650 596 528 600 600 528 650 234 500 430 756 800 234 288 258 1 28 494 450
ラウンジサイドテーブル 価格(税抜)サイズ(mm)梱包才数梱包重量 ASO-LT8050 120,800円 W800×D500×H4301.3才19.6kg 仕様/天板:抗ウイルスメラミン化粧板 (t22mm) 天板裏:抗ウイルスパッカ- 本体:抗ウイルスメラミン 化粧板 入数:1
ASO-LT8050(BR)
ASO-CF1260B(BR)
ASO-LT8050(MAK)
WH:ホワイト NA:ナチュラル MAK:ミディアムオーク BR:ブラウン ■天板カラーサンプル ラウンジテーブル 254
カフェテーブル
チェアデスク・収納パーティションテーブルレセプションロビーエクステリアアクセサリー木工

ワークテーブル

ラウンジ サイドテーブル


ASO-CF7575B(WH)
カフェテーブル

ASO-CF7575W(MAK)

ASO-CF750B(SGR)
価格(税抜)サイズ(mm)梱包才数梱包重量
ASO-CF7575B 69,000円 W750×D750×H7203.7才13kg
ASO-CF7575W 69,000円 W750×D750×H7203.7才13kg
仕様/天板:抗ウイルスメラミン化粧板 (t20mm) 抗ウイルスABSエッジ(SGRは通常ABS) 天板裏:抗ウイルス バッカ- 芯材:パ-ティクルボ-ド 脚:スチール 粉体塗装(B・ブラック、W・ホワイト) 入数:1(2個口)
価格(税抜)サイズ(mm)梱包才数梱包重量
ASO-CF750B 64,000円 φ750×H7203.7才11kg
ASO-CF750W 64,000円 φ750×H7203.7才11kg
仕様/天板:抗ウイルスメラミン化粧板 (t20mm) 抗ウイルスABSエッジ(SGRは通常ABS) 天板裏:抗ウイルス バッカ- 芯材:パ-ティクルボ-ド 脚:スチール 粉体塗装(B・ブラック、W・ホワイト) 入数:1(2個口)

ASO-CF750W(BR)
ASO-CF750B/W

ASO-WT6045B(BR)

ASO-WT6045B(MAK)

ASO-WT6045B(NA)
ワークテーブル 価格(税抜)サイズ(mm)梱包才数梱包重量
ASO-WT6045B
60,000円 W600×D450×H7202.2才15.7kg
仕様/天板:抗ウイルスメラミン化粧板 (t22mm) 抗ウイルスABSエッジ(SGRは通常ABS) 天板裏:抗ウイルスバッカ- 脚:スチ-ル 粉体塗装 (ブラック) 入数:1(2個口)

ASO-ST400B(NA)

ASO-ST400B(BR)

ASO-ST400B(SGR)

ASO-WT6045B(SGR)
ASO-WT6045B

ASO-ST4540B(WH)
ASO-ST400B
サイドテーブル 価格(税抜)サイズ(mm)梱包才数梱包重量
ASO-ST400B
ASO-ST4540B
仕様/天板:抗ウイルスメラミン化粧板
69,000円 φ440×H7202.2才15.4kg
71,000円 W450×D440×H7202.2才16.1kg
ASO-ST4540B
520 720 Φ750 520 720 □750 720 Φ400 Φ440 720 450 400 Φ440 400 450 720 600
カフェテーブル
脚:スチ-ル
(t22mm) 抗ウイルスABSエッジ(SGRは通常ABS) 天板裏:抗ウイルスバッカ-
粉体塗装 (ブラック) 入数:1(2個口)
使用例
使用例
ASO-CF7575B/W
255 SOCIA
幼保レンタル・リース
RO-SOR90(GN) RO-S1200(BL)

RO-NR600(BJ)(IV)
RO-SIR90(GN)
RO-SL90(BL)
RO-S1800(BL)
ROシリーズ 待合スペースに合わせてレイアウトが可能です。

背付きストレート 張地価格(税抜) サイズ(mm)


背付きストレート 張地価格(税抜) サイズ(mm) 梱包才数梱包重量
RO-S1200 レザー 151,000円 W1200×D640×H700 (SH400) ▲ 21.5才26kg
RO-S1200 布 162,000円 W1200×D640×H700 (SH400) ▲ 21.5才26kg
仕様/本体:木枠 入数:1

















400 1200 640 480 700 400 1800 640 480 700 400 600 640 480 700 背付きストレート 張地価格(税抜) サイズ(mm) 梱包才数梱包重量 RO-S1800 レザー 213,000円 W1800×D640×H700 (SH400) ▲ 32.0才 ▲ 35.8kg RO-S1800 布 237,000円 W1800×D640×H700 (SH400) ▲ 32.0才 ▲ 35.8kg 仕様/本体:木枠 入数:1
梱包才数梱包重量 RO-S600 レザー 81,000円 W600×D640×H700 (SH400) 10.9才14.6kg RO-S600 布 90,000円 W600×D640×H700 (SH400) 10.9才14.6kg
仕様/本体:木枠 入数:1
RO-S1800
アクセサリー PLK-11 P.286
RO-S1200
RO-S600
RO-S600(BL)
RO-S1200(OR) RO-S1800(IV)
GN:グリーン IV:アイボリー BL:ブルー BK:ブラック YE:イエロー BJ:ベージュ OR:オレンジ FGN:グリーン FBR:ブラウン FYE:イエロー FBL:ブルー FPK:ピンク FBK:ブラック FOR:オレンジ FBJ:ベージュ FLBL:ライトブルー ■カラーサンプル(布)
■カラーサンプル(PVC) 256
RO-S1800(YE)
システムソファ

左端
チェアデスク・収納パーティションテーブルレセプションロビーエクステリアアクセサリー木工

RO-SL90(BL)
中央 右端

RO-SC90(YE)
背付きコーナー 張地価格(税抜) サイズ(mm) 梱包才数梱包重量
RO-SL90 レザー 124,000円 W640×D640×H700 (SH400) 11.6才20.4kg
RO-SL90 布 140,000円 W640×D640×H700 (SH400) 11.6才20.4kg
RO-SC90 レザー 124,200円 W640×D640×H700 (SH400) 11.6才20.4kg
RO-SC90 布 140,400円 W640×D640×H700 (SH400) 11.6才20.4kg
RO-SR90 レザー 124,000円 W640×D640×H700 (SH400) 11.6才20.4kg
RO-SR90 布 140,000円 W640×D640×H700 (SH400) 11.6才20.4kg 仕様/本体:木枠 入数:1
コーナー(外)

背付き
外アールコーナー 張地価格(税抜) サイズ(mm) 梱包才数梱包重量
RO-SOR90 レザー 150,000円 W905×D640×H700 (SH400) 16.3才13.6kg
RO-SOR90 布 160,000円 W905×D640×H700 (SH400) 16.3才13.6kg
仕様/本体:木枠 入数:1
スツール

スツール 張地価格(税抜)サイズ(mm)梱包才数梱包重量
RO-N600 レザー 66,000円 W600×D600×H4006.0才12.2kg
RO-N600 布 70,000円 W600×D600×H4006.0才12.2kg 仕様/本体:木枠 入数:1
連結



コーナー(内)

背付き 内アールコーナー 張地価格(税抜) サイズ(mm) 梱包才数梱包重量
RO-SIR90 レザー 132,000円 W1115×D685×H700 (SH400) 21.3才22.6kg
RO-SIR90 布 146,000円 W1115×D685×H700 (SH400) 21.3才22.6kg
仕様/本体:木枠 入数:1
コーナースツール

コーナースツール 張地価格(税抜) サイズ(mm)梱包才数梱包重量
RO-NR600 レザー 62,000円 W600×D600×H4006.0才10.2kg
RO-NR600 布 65,000円 W600×D600×H4006.0才10.2kg
仕様/本体:木枠 入数:1

連結仕様
幼保レンタル・リース
アジャスターに共締めする形で連結 パーツを取り付けることでソファやス ツールを連結することが可能です。
400 600 600 400 600 600 R600 400 640 480 640 480 700 400 790 480 640 700 90° R790 400 640 480 640 480 700 640 480 90° R640 400 700 400 640 480 640 480 700
RO-SOR90(GN)
RO-SIR90(GN)
RO-SR90(BL)
オス メス
RO-N600(BJ)
RO-NR600(IV)
RO-N600
RO-SOR90
RO-NR600
RO-SIR90
RO-SR90
RO-SC90
RO-SL90
257 SOCIA
ロビーチェア

1RD-52(布/ライトグリーン) 117,000円(税抜)
2RD-42C(布/ライトグリーン) 111,000円(税抜)
RDシリーズ


RD-52C(合成皮革/ライトブラウン)
ロビーチェア 張地価格(税抜) サイズ(mm) 梱包才数梱包重量
RD-52C レザー 142,000円
RD-52C 布 148,000円
RD-52 レザー 111,000円
RD-52 布 117,000円
W1480×D580×H780(SH395)9.8才26kg
W1480×D580×H780(SH395)9.8才26kg
W980×D580×H780(SH395)9.7才22kg
W980×D580×H780(SH395)9.7才22kg
仕様/座:成型合板 脚:アルミダイカスト 天板:メラミン化粧板 (t19mm) 入数:1(3個口)














3RD-53(布/ライトグリーン) 147,000円(税抜)
■オプション アンカーボルト止め金具
ABT4
11,000円(税抜) サイズ:W60×D25×H13mm 穴 径:φ13mm 本 体:スチール 入 数:1セット ●1セット=4個
580 395 1480 480 780 268 1206 435 □450 395 580 395 980 480 780 268 706 435
RD-52C
RD-52(布/ライトグリーン)
ライトイエロー グレー ライトグリーン ネイビー
ダークブラウン アイボリー グレー ライトグリーン ダークブルー ネイビー ライトシルバー ■カラーサンプル 布 ライトブラウン
ライトアイボリー 合成皮革
258
RD-52
RD-53(布/ライトシルバー)


RD-54(合成皮革/ネイビー)
RD-53 RD-54
ロビーチェア 張地 価格(税抜) サイズ(mm) 梱包才数梱包重量
RD-53 レザー 137,000円 W1480×D580×H780(SH395)9.8才29kg
RD-53 布 147,000円 W1480×D580×H780(SH395)9.8才29kg
RD-54 レザー 167,000円 W1980×D580×H780(SH395)10.2才34kg
RD-54 布 180,000円 W1980×D580×H780(SH395)10.2才34kg 仕様/座:成型合板 脚:アルミダイカスト 入数:1(3個口)

RD-42(布/グレー)
RD-42C(合成皮革/ライトイエロー)

ロビーチェア 張地 価格(税抜) サイズ(mm) 梱包才数梱包重量
RD-42C レザー 109,000円 W1500×D500×H425(SH400)3.7才19kg
RD-42C 布 111,000円 W1500×D500×H425(SH400)3.7才19kg
RD-42 レザー 78,000円 W1000×D500×H425(SH400)3.7才17kg
RD-42 布 80,000円 W1000×D500×H425(SH400)3.7才17kg 仕様/座:成型合板 脚:アルミダイカスト 天板:メラミン化粧板 (t19mm) 入数:1(3個口)

RD-43(合成皮革/ライトブラウン)

RD-44(布/ダークブラウン)
ロビーチェア 張地 価格(税抜) サイズ(mm) 梱包才数梱包重量
RD-43 レザー 93,000円 W1500×D500×H425(SH400)3.7才20kg
RD-43 布 96,000円 W1500×D500×H425(SH400)3.7才20kg
RD-44 レザー 113,000円 W2000×D500×H425(SH400)4.7才23kg
RD-44 布 118,000円 W2000×D500×H425(SH400)4.7才23kg
仕様/座:成型合板 脚:アルミダイカスト 入数:1(3個口)
500 425 1000 500 268 706 400 500 425 1500 500 268 382 1206 400 □450 500 425 1500 500 268 1206 400 500 425 2000 500 268 1706 400 580 395 1480 480 780 268 1206 435 580 395 1980 480 780 268 1706 435
RD-44
RD-43
RD-42C RD-42
259 SOCIA
幼保レンタル・リース
チェアデスク・収納パーティションテーブルレセプションロビーエクステリアアクセサリー木工
KUMIKIスツール

腰掛にもテーブルにもなる収納できるボックス型スツール。
お好みのレイアウトにアレンジが可能。
箱本体



■カラーサンプル

NA : ナチュラル

WN : ウォールナット

箱 価格(税抜)サイズ(mm)梱包才数梱包重量
KUMI-450H 48,900円 W450×D450×H4254.2才9kg
仕様/本体:パ-ティクルボ-ド ポリエステル化粧板 小口テ-プ貼り アジャスタ-:ポリエチレン 入数:1 ●内寸:W405×D405×H390 ●上下連結4個付、横連結ボルト2個付
テーブル天板


天板 価格(税抜)サイズ(mm)梱包才数梱包重量
KUMI-450T 11,900円 W450×D450×H170.2才3kg
KUMI-900T 14,700円 W900×D450×H170.2才3kg
仕様/天板:合板/ポリエステル化粧板 小口/テ-プ貼り 入数:1
箱 価格(税抜)サイズ(mm)梱包才数梱包重量
KUMI-900H 61,400円 W900×D450×H4258.2才14kg 仕様/本体:パ-ティクルボ-ド ポリエステル化粧板 小口テ-プ貼り アジャスタ-:ポリエチレン 入数:1 ●内寸:W855×D405×H390 ●上下連結8個付、横連結ボルト2個付
ポイント

■天板カラー

WH : ホワイト
収納容量
450H(内寸405×405×390) は約60ℓ、900H(内寸895× 405×390)は約135ℓの収納 量があります。 使用環境に応じた備品や生活 必需品の保管、防災関連グッズ 等の収納に重宝します。
KUMI-450H(NA)
KUMI-450H(WN)
KUMI-450T(WH)
KUMI-900T(WH)
KUMI-900H(WN)
KUMI-900H(NA)
KUMI-H900(NA)+KUMI-900F(GJ)
260
KUMI-H900(WN)+KUMI-900F(TQ)
チェアデスク・収納パーティションテーブルレセプションロビーエクステリアアクセサリー木工

セット例





KUMI-900H(WN)+KUMI-900F(BJ)
■クッションカラー(布)
クッション(布)


クッション(レザー)





スペイン製 Fabric
※張地メンテナンス方法は、P053をご覧下さい。 ※製法の特製上、繊維の流れる方向により、色が異なって見え ることがあります
クッション (布張) 価格(税抜)サイズ(mm)梱包才数梱包重量
KUMI-450F(GJ/TQ) 17,900円 W450×D450×H400.5才3kg
KUMI-900F(GJ/TQ) 27,800円 W900×D450×H401.0才5kg
仕様/クッション:合板 スラブウレタン+チップウレタン 布張り 入数:1


クッション (PVC張) 価格(税抜)サイズ(mm)梱包才数梱包重量
KUMI-450F(BJ/GN) 15,900円 W450×D450×H400.5才3kg
KUMI-900F(BJ/GN) 23,800円 W900×D450×H401.0才5kg
仕様/クッション:合板 スラブウレタン+チップウレタン 合成皮革 (PVC) 入数:1
連結



幼保レンタル・リース
KUMI-450H(WN)+KUMI-450F(TQ)
KUMI-450H(NA)+KUMI-450F(GN)
KUMI-450H(WN)+KUMI-450T(WH)
KUMI-900H(NA)+KUMI-900F(GJ)
KUMI-900H(NA)+KUMI-900T(WH)
KUMI-450F(GJ)
KUMI-450F(BJ)
KUMI-900F(GN)
上下連結
KUMI-900F(TQ)
横連結
複合連結
TQ:ターコイズ GJ:グレージュ
GN:グリーン BJ:ベージュ
■クッションカラー(レザー)
261 SOCIA
キッズガーデン

スツール

お子さまに配慮した防汚、抗菌、耐次亜塩素酸対応。
レザー張りキッズガーデン。

スツール・シューズBOX 価格(税抜)サイズ(mm)梱包才数梱包重量
KID-1150 54,000円 W1150×D250×H2502.9才9kg
KID-900 45,000円 W900×D250×H2502.3才7.5kg
仕様/張地:合成皮革 クッション材:ウレタンフォ-ム 本体:ポリエステル化粧板 (シュ-ズBOXのみ) 入数:1
シューズBOX

キッズガーデン スツール・シューズBOX 価格(税抜)サイズ(mm)梱包才数梱包重量
KID-B925 115,000円 W900×D250×H2502.3才7.5kg
仕様/張地:合成皮革 クッション材:ウレタンフォ-ム 本体:ポリエステル化粧板 (シュ-ズBOXのみ) 入数:1
■張地カラーサンプル

BL:ブルー

OR:オレンジ

GN:グリーン

YE:イエロー
マット(入口・コーナー) クッション



クッション 価格(税抜)サイズ(mm)梱包才数梱包重量
KID-K10 17,000円 φ200×H2000.4才1kg
KID-K20 18,000円 △200×H2000.4才1kg
KID-K30 17,000円 〼200×H2000.4才1kg
仕様/張地:合成皮革 クッション材:ウレタンフォ-ム 入数:1



マット (入口・コーナー) 価格(税抜)サイズ(mm)梱包才数梱包重量
KID-C1150 75,000円 W1150×D1150×H402.5才8.5kg
KID-I250 24,000円 W900×D250×H400.4才2.3kg
KID-M90 38,000円 W900×D900×H401.5才5.6kg
仕様/張地:合成皮革 クッション材:ウレタンフォ-ム 入数:1
KID-1150(OR)
KID-900(OR)
KID-B925(OR)
KID-K10(OR)
KID-K20(GN)
KID-K30(BL)
KID-M90(GN)
KID-C1150(YE)
KID-I250(OR)
KID-1150 54,000円 ×3 KID-900 45,000円 ×2 KID-B925 115,000円 ×1 KID-C1150 75,000円 ×1 KID-M90 38,000円 ×3 合計 556,000
262
円
絵本ラック


ブックエンド
可動棚にはブックエンドを 取り付けることが可能。

可動棚 10mmピッチで棚板を動かす ことが可能。

抗ウイルスに対応したブックラックシリーズ


絵本ラックスタンド 価格(税抜)サイズ(mm)梱包才数梱包重量 ENR-S 98,000円 W890×D300×H9002.1才20kg
仕様/本体:抗ウイルスプリント紙化粧板貼り 入数:1 ●可動棚3枚付 (10mmピッチ)
絵本ラックオープン 価格(税抜)サイズ(mm)梱包才数梱包重量
ENR-O 94,000円 W890×D300×H9002.1才17.4kg
仕様/本体:抗ウイルスプリント紙化粧板貼り 入数:1 ●可動棚3枚付 (10mmピッチ)


絵本ラックkumiki 価格(税抜)サイズ(mm)梱包才数梱包重量 ENR-K 82,000円 W800×D400×H8202.0才19kg
仕様/本体:抗ウイルスプリント紙化粧板貼り 入数:1
箱 クッション



箱 価格(税抜)サイズ(mm)梱包才数梱包重量
KUMI-350H 47,500円 W350×D350×H4254.2才6.9kg
仕様/本体:パ-ティクルボ-ド ポリ化粧板 小口テ-プ貼り アジャスタ-:ポリエチレン 入数:1





幼保レンタル・リース
クッションPVC張り 価格(税抜)サイズ(mm)梱包才数梱包重量
KUMI-350F 15,100円 W350×D350×H400.3才1.7kg 仕様/クッション:合板 スラブウレタン+チップウレタン 合成皮革 (PVC) 入数:1


NA:ナチュラル IV:アイボリー ■カラーサンプル
ENR-K+KUMI-350H(IV)×2+KUMI-350F(GN)×2
KUMI-350H(IV)
KUMI-350H(NA)
KUMI-350F(BJ)
コーナーキャップ 本体収納 ENR-K
ENR-S
KUMI-350F(GN)
ENR-O
GN:グリーン BJ:ベージュ ■カラーサンプル 263 SOCIA
チェアデスク・収納パーティションテーブルレセプションロビーエクステリアアクセサリー木工
ラウンジソファ

ASO-LS


ASO-LS600S(LGN)


ASO-LS600S(PK)




BJ:ベージュ
■カラーサンプル ※製法の特性上、繊維の流れる方向により、色が異なって見えることがあります。

ASO-LS600N(LGN)

ASO-LS600N(BJ)

ASO-LS600N(PK)

ASO-LS600N(BL)
ラウンジソファ 価格(税抜)
サイズ(mm)梱包才数梱包重量
ASO-LS600S 110,000円 W600×D600×H750 (SH435)10.1才16.9kg
仕様/張地:布 (ポリエステル) 座:木枠 フレ-ム:天然木 (タモ材) ポリウレタン塗装 入数:1(2個口)
ラウンジソファ 価格(税抜) サイズ(mm)梱包才数梱包重量
ASO-LS600N 94,000円 W600×D600×H4355.3才14.8kg
仕様/張地:布 (ポリエステル) 座:木枠 フレ-ム:天然木 (タモ材) ポリウレタン塗装 入数:1(2個口)
□600 435 15 1 750 600 450 600 435 15 1
ASO-LS600S
ASO-LS600N
PK:ピンク
LGN:ライトグリーン
BL:ブルー
ASO-LS600S(BJ)
ASO-LS600S(BL)
ASO-LS600S(PK)
ASO-LS600S(BJ)
ASO-CF750W(MAK)
ASO-LS600N(LGN)
ASO-CF1260W(NA)
ASO-LS600S(BL)
264
同系色2トーンカラーのロビーベンチ
張地の機能も豊富で、光沢感のある2トーンカラーのロビーベンチ。



■カラーサンプル(ZZW)








ZZW・ZZ LZ・LZS

ロビーチェア 価格(税抜) サイズ(mm) 梱包才数梱包重量
ZZW-1500 118,000円 W1500×D580×H640 (SH420)15.2才26kg
ZZW-1800 133,000円 W1800×D580×H640 (SH420) ▲ 19.1才28kg
仕様/座:木枠 合成皮革 (PVC) 脚:スチ-ル (〼31mm) 粉体塗装 (シルバ-) 入数:1





■カラーサンプル(LZ・LZS)





ロビーチェア背無し 価格(税抜) サイズ(mm) 梱包才数梱包重量
ZZ-1500 75,000円 W1500×D580×H4207.5才20kg
ZZ-1800 86,000円 W1800×D580×H420 ▲ 9.0才22kg
仕様/座:木枠 合成皮革 (PVC) 脚:スチ-ル (〼31mm) 粉体塗装 (シルバ-) 入数:1




ロビーチェア 価格(税抜) サイズ(mm) 梱包才数梱包重量
LZS-1500 110,000円 W1500×D580×H640 (SH420)15.2才26kg
LZS-1800 122,000円 W1800×D580×H640 (SH420) ▲ 19.1才28kg
LZ-1500 68,000円 W1500×D580×H420 7.5才20kg
LZ-1800 80,000円 W1800×D580×H420 ▲ 9.0才22kg
仕様/座:木枠 合成皮革(PVC) 脚:スチ-ル (〼31mm) 粉体塗装 (シルバ-) 入数:1
420 1800/1500 1720/1420 31 0 495 580 580 420 1800/1500 1720/1420 31 0 495 640 420
ZZW-1800(GN)
ZZ-1800(GN)
LZS-1500(BK)
LZ-1500(BK)
LZS-1800(IV)
LZ-1800(PK)
LZS-1500(BL)
LZ-1500(GN)
ZZ-1800(PK)
ZZ-1500(BR)
ZZW-1800(PK)
背無 ZZ-1800/1500 LZ-1800/1500 背付 ZZW-1800/1500 LZS-1800/1500
ZZW-1500(BR)
BK:ブラック PK:ピンク IV:アイボリー GN:グリーン BL:ブルー
背 座
PK:ピンク PK:ピンク GN:グリーン GN:グリーン BR:ブラウン BR:ブラウン PK:ピンク GN:グリーン BR:ブラウン
265 SOCIA
幼保レンタル・リース
■カラーサンプル(ZZ) 座
チェアデスク・収納パーティションテーブルレセプションロビーエクステリアアクセサリー木工
屋外ベンチ

自然で優しい木目調の樹脂ベンチ。
座板は、再生樹脂と耐候性に優れた樹脂の2層構造。
JA 樹脂ベンチ

樹脂ベンチ 価格(税抜)
サイズ(mm)梱包才数梱包重量
JA-1 234,800円 W1800×D580×H770 (SH385) 6.5才 ▲ 63kg
仕様/背・座 表面被:ASA樹脂 内部:ABS樹脂 (再生100%) 脚:鉄鋳物
注意
色調に誤差が生じる事があります。
■カラーサンプル


樹脂ベンチ 価格(税抜) サイズ(mm)梱包才数梱包重量
JA-1A 246,800円 W1900×D580×H770 (SH385) 7.5才 ▲ 69kg
仕様/背・座 表面被:ASA樹脂 内部:ABS樹脂 (再生100%) 脚・肘:鉄鋳物 粉体塗装 入数:1(4個口)

1690 (アンカーボルト穴ピッチ) 506 (アンカーボルト穴ピッチ) 1660 385 770 1800 410 580 305 580 61 0 1900 1690 (アンカーボルト穴ピッチ) 506 (アンカーボルト穴ピッチ) 1660 385 770 1800 410 580 305 580
粉体塗装 入数:1(3個口)
JA-2N
JA-1A
JA-1
JAベンチには、脚にアンカーボルト用の 穴が設けてあります。 穴径:φ12mm
JA-1A
266
レンタル・リース Rental / Lease
Exterior Accessories Woodworking Welfare Kindergarten
中肘は寝ころび防止としても使用出来ます
チェアデスク・収納パーティションテーブルレセプションロビーエクステリアアクセサリー木工

樹脂ベンチ 価格(税抜) サイズ(mm)梱包才数梱包重量
JA-1N 256,000円 W1800×D580×H770 (SH385) 6.9才 ▲ 68kg
仕様/背・座 表面被:ASA樹脂 内部:ABS樹脂 (再生100%) 脚・肘:鉄鋳物 粉体塗装 入数:1(4個口)
注意
色調に誤差が生じる事があります。

樹脂ベンチ 価格(税抜) サイズ(mm)梱包才数梱包重量
JA-1AN 264,000円 W1900×D580×H770 (SH385) 7.4才 ▲ 75kg 仕様/背・座 表面被:ASA樹脂 内部:ABS樹脂 (再生100%) 脚・肘:鉄鋳物 粉体塗装 入数:1(5個口)


樹脂ベンチ 価格(税抜) サイズ(mm)梱包才数梱包重量
JA-2 155,600円 W1800×D485×H410 (SH400) 3.4才46kg
仕様/座 表面被:ASA樹脂 内部:ABS樹脂 (再生100%) 脚:鉄鋳物 粉体塗装 入数:1(2個口)
注意
色調に誤差が生じる事があります。

JAベンチには、脚にアンカーボルト用の 穴が設けてあります。 穴径:φ12mm

幼保レンタル・リース
樹脂ベンチ 価格(税抜) サイズ(mm)梱包才数梱包重量
JA-2N 174,000円 W1800×D485×H615 (SH400) 5.4才48kg 仕様/座 表面被:ASA樹脂 内部:ABS樹脂 (再生100%) 脚・肘:鉄鋳物 粉体塗装 入数:1(3個口)
770 1900 560 410 580 61 0 1690 (アンカーボルト穴ピッチ) 506 (アンカーボルト穴ピッチ) 1660 385 305 580 590 590 770 1800 560 410 580 61 0 1690 (アンカーボルト穴ピッチ) 506 (アンカーボルト穴ピッチ) 1660 385 305 580 590 590 41 0 1800 435 400 1690 (アンカーボルト穴ピッチ) 412 (アンカーボルト穴ピッチ) 1660 305 485 41 0 400 1690 (アンカーボルト穴ピッチ) 412 (アンカーボルト穴ピッチ) 1660 305 485 61 5 1800 560 590 590 435
JA-1N
JA-1AN
JA-2
JA-2N
267 SOCIA
JA-2N
屋外ベンチ

楽器に用いられるニャトー材(南洋桜)を使用したベンチ。 表面の仕上げはオイルフィニッシュ。
CWウッドベンチ

ウッドベンチ 価格(税抜) サイズ(mm)梱包才数梱包重量
CW-1 222,000円 W1800×D650×H753 (SH347) 5.3才58.2kg 仕様/背・座:天然木 防腐処理 脚:鉄鋳物 粉体塗装 (ダ-クグレ-) 入数:1(3個口) ●背板・座板サイズ:W1800×D80×H40×10枚

ウッドベンチ 価格(税抜) サイズ(mm)梱包才数梱包重量
CW-1A 243,000円 W1900×D650×H753 (SH347) 5.7才 ▲ 67.5kg 仕様/背・座:天然木 防腐処理 脚・肘:鉄鋳物 粉体塗装 (ダ-クグレ-) 入数:1(4個口) ●背板・座板サイズ:W1800×D80×H40×10枚

ウッドベンチ 価格(税抜) サイズ(mm)梱包才数梱包重量 CW-2 148,000円 W1800×D515×H3902.8才37.6kg 仕様/座:天然木 防腐処理 脚:鉄鋳物 粉体塗装 (ダ-クグレ-) 入数:1(2個口) ●座板サイズ:W1800×D80×H40×6枚

CW-1/1A/2の脚には アンカーボルト止め用の穴があいています 穴径:φ11mm
◎注意事項
・本製品は天然木のため、使用状況によって色落ち する場合がありますので、定期的なメンテナンスを お勧め致します。
・本製品は天然木のため、色・柄が異なる場合があ ります。
・完成品発送の場合はお問い合わせください。 別途費用(組立費、梱包費、運賃、搬入費)の お見積りを致します。
753 1800 1670 (アンカーボルト穴ピッチ) 1625 347 428 650 456 (アンカーボルト穴ピッチ) 556 1780 540 428 650 753 347 1670 (アンカーボルト穴ピッチ) 456 (アンカーボルト穴ピッチ) 1625 556 1900 515 390 1670 (アンカーボルト穴ピッチ) 320(アンカーボルト穴ピッチ) 1625 420 1800
CW-1A
CW-2
CW-1
CW-2
CW-1A
268

ウッドベンチ
チェアデスク・収納パーティションテーブルレセプションロビーエクステリアアクセサリー木工

ウッドベンチ 価格(税抜) サイズ(mm)梱包才数梱包重量
CW-11 145,000円 W1500×D580×H670 (SH355) 2.9才37kg 仕様/背・座:天然木 防腐処理 脚:鉄鋳物 粉体塗装 (ダ-クグリ-ン) 入数:1(2個口) ●背板・座板サイズ:W1465×D80×H30×8枚

ウッドベンチ 価格(税抜) サイズ(mm)梱包才数梱包重量
CW-11A 154,000円 W1500×D580×H670 (SH355) 2.9才42.7kg
仕様/背・座:天然木 防腐処理 脚:鉄鋳物 粉体塗装 (ダ-クグリ-ン) 入数:1(2個口)
●背板・座板サイズ:W1465×D80×H30×8枚

ウッドベンチ 価格(税抜) サイズ(mm)梱包才数梱包重量
CW-12 118,000円 W1500×D570×H395 (SH390) 2.1才30.7kg
仕様/座:天然木 防腐処理 脚:鉄鋳物 粉体塗装 (ダ-クグリ-ン) 入数:1(2個口) ●座板サイズ:W1465×D80×H30×6枚
■オプション

アンカーボルト止め金具 穴径:φ13mm
アンカーボルト止め金具 価格(税抜価格)サイズ(mm)
ABT4 11,000円 W60×D25×H13
仕様/穴 径:φ13mm 本体:スチ-ル 入数:1 ●1セット=4個

ウッドベンチ 価格(税抜) サイズ(mm)梱包才数梱包重量 SW-480 99,000円 W1800×D480×H4204.6才38kg 仕様/座:天然木 防腐処理 脚:スチ-ル 粉体塗装 (グレ-) 入数:1(2個口) ●座板サイズ:W1800×D80×H40×6枚
幼保レンタル・リース
670 355 430 580 1500 1471 490 544 670 355 430 580 1500 1471 490 544 550 395 1500 1471 490 540 390 570 550 180 370 180 1800 1440 80 480 420
CW-11
CW-11A
CW-12
SW-480
269 SOCIA
折り畳みカラーベンチ (バネ脚式・背なし)
バネ機構により開閉時に脚がしっかりと固定されます。
使用中や持ち運びの際に不用意に脚が開閉しない安全設計です。

折畳みカラーベンチ 価格(税抜) サイズ(mm)梱包才数梱包重量
FB-3S 53,000円 W1805×D415×H4002.3才17.3kg
仕様/座:樹脂成型品 (ブル-) 脚:スチ-ル (〼26mm) 粉体塗装 入数:1
●折畳時:W1805×D415×H70
折り畳みカラーベンチ (背付き)

折畳みカラーベンチ (背付) 価格(税抜) サイズ(mm)梱包才数梱包重量
FB-1B 89,000円 W1805×D445×H700 (SH390) 4.6才26kg
仕様/背・座:樹脂成型品 (ブル-) 脚:スチ-ル (〼26mm) メラミン焼付塗装 入数:1
●折畳時:W1805×D445×H145 ●背板名入れ有効寸:W1770×H185

衝撃などによる脚の折畳みが 起こりにくいバネ脚。
バネの力でしっかりと脚を開き、設置することがで きます。スライド式やクランク式に比べ、使用時 の脚の折畳みが起こりにくい安全性の高い仕様 です。

折畳みカラーベンチ 価格(税抜) サイズ(mm)梱包才数梱包重量
FB-4S 48,000円 W1505×D415×H4002.1才13.5kg
仕様/座:樹脂成型品 (ブル-) 脚:スチ-ル (〼26mm) 粉体塗装 入数:1 ●折畳時:W1505×D415×H70


折畳みカラーベンチ (背付) 価格(税抜) サイズ(mm)梱包才数梱包重量
FB-2B 78,000円 W1505×D445×H700 (SH390) 3.8才21kg 仕様/背・座:樹脂成型品 (ブル-) 脚:スチ-ル (〼26mm) メラミン焼付塗装 入数:1 ●折畳時:W1505×D445×H145 ●背板名入れ有効寸:W1470×H185
折り畳み時 395 445 354 1805 1470 390 700 445 1805 145 395 445 354 1505 1170 390 700 445 1505 145 折り畳み時 415 345 365 1805 1540 400 70 折り畳み時 415 345 365 1505 1240 400 70 折り畳み時
FB-3S(BL)
FB-1B(ブルー)
FB-4S(BL)
FB-2B(ブルー)
ベンチ 270
FB-1B(ブルー)折り畳み時
カラーベンチ スタンダードタイプ (背なし)
チェアデスク・収納パーティションテーブルレセプションロビーエクステリアアクセサリー木工

B-4(1800)
カラーベンチ (背なし) 価格(税抜) サイズ(mm)梱包才数梱包重量 B-4(1800) 47,000円 W1805×D410×H4002.1才16.6kg
仕様/座:樹脂成型品 (ブル-) 脚:スチ-ル (〼26mm) 粉体塗装 入数:1

B-4(1500)
カラーベンチ (背なし) 価格(税抜) サイズ(mm)梱包才数梱包重量
B-4(1500) 41,000円 W1505×D410×H4001.8才13kg
仕様/座:樹脂成型品 (ブル-) 脚:スチ-ル (〼26mm) 粉体塗装 入数:1
B-4(1800)
カラーベンチ スタンダードタイプ (背付き)

カラーベンチ (背付) 価格(税抜) サイズ(mm)梱包才数梱包重量
B-3(1800) 63,000円 W1805×D505×H700 (SH400) 3.0才23kg
仕様/背・座:樹脂成型品 (ブル-) 脚:スチ-ル (〼26mm) 粉体塗装 入数:1
●背板名入れ有効寸:W1770×H185
B-4(1500)

B-3(1500)
カラーベンチ (背付) 価格(税抜) サイズ(mm)梱包才数梱包重量
B-3(1500) 53,000円 W1505×D505×H700 (SH400) 2.6才19kg
仕様/背・座:樹脂成型品 (ブル-) 脚:スチ-ル (〼26mm) 粉体塗装 入数:1
●背板名入れ有効寸:W1470×H185
名入れ承ります(別注対応)
(例)

カラーベンチ背付タイプの上下の背板部分に カッティング文字を入れることができ、 内容をアピールできます(文字入はオプションです。)
幼保レンタル・リース
適応機種背板 名入れ有効寸法
B-3(1500) W1470×H185
B-3(1800) W1770×H185
FB-1B(ブルー) W1770×H185
FB-2B(ブルー) W1505×H185
400 505 1505 1148 400 700 400 505 1805 1265 400 700 410 1505 1148 400 420 410 1805 1265 400 420
B-3(1800)
B-3(1800)
B-3(1500)
271 SOCIA
ベンチ
アルミベンチ スタンダード

アルミベンチ (背付) 価格(税抜) サイズ(mm)梱包才数梱包重量
ALB-5 104,000円 W1800×D505×H700 (SH395) 3.4才16kg 仕様/本体:アルミ アルマイト仕上げ 入数:1

アルミベンチ (背なし) 価格(税抜) サイズ(mm)梱包才数梱包重量
ALB-6 74,000円 W1800×D410×H400 2.2才12kg
仕様/本体:アルミ アルマイト仕上げ 入数:1
折り畳みアルミベンチ

バネ脚折畳み
アルミベンチ (背なし) 価格(税抜) サイズ(mm)梱包才数梱包重量
AFB-1S 88,000円 W1800×D410×H4203.2才12kg
仕様/本体:アルミ アルマイト仕上げ 入数:1 ●折畳時:W1800×D410×H95
折り畳み木製ベンチ

木製ベンチ 価格(税抜) サイズ(mm)梱包才数梱包重量
MB-1830 43,000円 W1800×D300×H4003.2才13kg
仕様/座板:合板 (t21mm) ソフトエッジ (ブラック) フレ-ム:スチ-ル 粉体塗装 入数:1
バネ機構により開閉時に脚がしっかりと固定されます。
使用中や持ち運びの際に不用意に脚が開閉しない安全設計です。

木製ベンチ 価格(税抜) サイズ(mm)梱包才数梱包重量
MB-1530 42,000円 W1500×D300×H4002.6才10kg
仕様/座板:合板 (t21mm) ソフトエッジ (ブラック) フレ-ム:スチ-ル 粉体塗装 入数:1
折り畳み時 410 420 1800 1495 365 95 413 478 395 1800 1350 700 505 410 400 1800 1350 233 300 353 1380 400 74 1500 折り畳み時 84 233 300 353 1680 400 74 1800 折り畳み時 84
ALB-5
ALB-6
AFB-1S
MB-1830
MB-1530
272
パラソル
チェアデスク・収納パーティションテーブルレセプションロビーエクステリアアクセサリー木工

FAP


パラソル 価格(税抜)サイズ(mm)梱包才数梱包重量
FAP-210 90,000円 φ2100×H23602.1才 23kg 仕様/支柱:アルミ 傘部:ポリエステル 入数:5 ●支柱径:φ32 ●骨数:12本
GA-S

幼保レンタル・リース
パラソルスタンド 価格(税抜)サイズ(mm)梱包才数梱包重量 GA-S33 43,000円 W490×D490×H4664.4才 13kg 仕様/本体:スチ-ル 粉体塗装 入数:1 ●差込口:φ33.5
AL-W53AC(BR)
AL-F90RT(BR)
FAP-210(WH)
GA-S33
FAP-210(BJ)
GA-S33
FAP-210(WH)
FAP-210(BJ)
273 SOCIA

AL-P


アルミチェア 価格(税抜) サイズ(mm)梱包才数梱包重量
AL-P40C 28,300円 W425×D555×H795 (SH430)15.0才16kg
仕様/背・座:樹脂成型品 フレ-ム:アルミ アルマイト 入数:4 ●屋外使用可能 ●スタッキング可能 (4脚まで)
アルミアームチェア 価格(税抜) サイズ(mm)梱包才数梱包重量
AL-P53AC 30,400円 W550×D560×H715 (SH430)14.0才15kg
仕様/背・座:樹脂成型品 フレ-ム:アルミ アルマイト 入数:4 ●屋外使用可能 ●スタッキング可能 (4脚まで)


木目柄の樹脂成型品を使用 木目調の樹脂成型品を使用しているので、 見た目は天然木のような印象。雨にも強い ので、屋外での使用に最適です。
アルミテーブル 価格(税抜)サイズ(mm)梱包才数梱包重量
AL-P60RT 35,700円 φ600×H7251.8才 8kg
仕様/天板:樹脂成型品 支柱:アルミ アルマイト (φ60mm) 脚:アルミダイカスト 入数:1 ●屋外使用可能
555 450 430 795 420 (座) 380(背) スタッキング/ 4脚 700 1180 425 560 432 430 550 715 スタッキング/ 4脚 590 1020 Φ600 580 725
AL-P60RT
AL-P53AC
AL-P60RT
AL-P40C AL-P40C
AL-P60RT アルミチェア・テーブル 274
AL-P53AC
AL-P53AC
アルミテーブル/チェア
AL-F
チェアデスク・収納パーティションテーブルレセプションロビーエクステリアアクセサリー木工

AL-F90RT(BR)

AL-F90RT(AL)
アルミフォールディング テーブル 価格(税抜)サイズ(mm)梱包才数梱包重量
AL-F90RT 60,000円 φ900×H72510.5才 11kg 仕様/天板:アルミ 粉体塗装 フレ-ム:アルミ アルマイト・フレ-ム:アルミ 粉体塗装 入数:1 ●折畳時サイズ:W900×D255×H1135 ●屋外使用可能
AL-53AC

AL-53AC
アルミアームチェア 価格(税抜) サイズ(mm)梱包才数梱包重量
AL-53AC 24,000円 W530×D560×H710 (SH415)14.0才15kg 仕様/フレ-ム:アルミ アルマイト (φ25.4mm) 背・座:アルミ アルマイト 入数:4 ●屋外使用可能 ●スタッキング可能 (4脚まで)

折畳んでも自立します。 テーブルは折畳みが可能。 折畳み時も自立するので、 収納にも手間を取りません。
折り畳みサイズ W900×D255×H1135mm

パラソル穴付き AL-F90RTの天板には、パラソル穴が付いています。 (パラソル穴:φ45mm、32mm) ※パラソルをご使用になる際は、必ずパラソルスタンドを 使用してください。転倒する恐れがあります。
AL-W53AC

AL-W53AC(BR)

PEコードの編込成型 背と座は、平らなポリエチレンコードを編 み込んで成型しており、座った際は体に なじみも良く、見た目もスタイリッシュ。
幼保レンタル・リース
アルミアームチェア 価格(税抜) サイズ(mm)梱包才数梱包重量
AL-W53AC 29,400円 W545×D580×H820 (SH435)17.5才15kg 仕様/フレ-ム:アルミ 粉体塗装 背・座:PEコ-ド 入数:4 ●屋外使用可能 ●スタッキング可能 (4脚まで)
Φ900 720 725 715 255 1135 折り畳み時 560 443 415 530 710 590 1015 スタッキング/ 4脚 スタッキング/ 4脚 580 485 435 545 820 660 770 1095
275 SOCIA
Accessories
傘立て
Woodworking Welfare Kindergarten
K-102S、KVO102(SV)


Rental / Lease
スチール 傘立て

傘立て 価格(税抜)サイズ(mm)梱包才数梱包重量 K-27T 18,900円 W270×D300×H5000.5才3kg
仕様/本体:スチ-ル (〼22mm) 粉体塗装 (ブラック) 傘枠:スチ-ル 粉体塗装 (ブラック) 差 込口:W65×D80mm×9個 受皿:樹脂成型品 (ブラック) 入数:1 ●9本収納 受皿枚数: (小) 1枚 ●受皿 (大) (小) のみの注文も対応致します。詳細はお問合わせ下さい。

傘立て 価格(税抜)サイズ(mm)梱包才数梱包重量 K-48T 19,500円 W485×D300×H5000.6才4kg 仕様/本体:スチ-ル (〼22mm) 粉体塗装 (ブラック) 傘枠:スチ-ル 粉体塗装 (ブラック) 差 込口:W80×D80mm×15個 受皿:樹脂成型品 (ブラック) 入数:1 ●15本収納 受皿枚数: (大) 1枚 ●受皿 (大) (小) のみの注文も対応致します。詳細はお問合わせ下さい。
K-92T K-102T
傘立て 価格(税抜)サイズ(mm)梱包才数梱包重量
K-92T 24,900円 W920×D300×H5000.9才5kg 仕様/本体:スチ-ル (〼22mm) 粉体塗装 (ブラック) 傘枠:スチ-ル 粉体塗装 (ブラック) 差込口: W80×D80mm×30個 受皿:樹脂成型品 (ブラック) 入数:1 ●30本収納 受皿枚数:(大) 2枚 ●受皿 (大) (小) のみの注文も対応致します。詳細はお問合わせ下さい。
傘立カバー

KVO48(SV)+K-48T
傘立てオプションカバー 価格(税抜)サイズ(mm)梱包才数梱包重量
KVO27 9,000円 W267×D110×H4850.6才3.8kg
KVO48 12,300円 W482×D110×H4851.1才5.6kg
仕様/本体:スチ-ル メラミン焼付塗装 入数:1 ●KVO27(SV):KS-27、K-27S、K-27Tに対応・ ●KVO48(SV):KS-48、K-48S、K-48Tに対応

傘立て 価格(税抜)サイズ(mm)梱包才数梱包重量 K-102T 29,200円 W1360×D300×H5001.5才7.1kg 仕様/本体:スチ-ル (〼22mm) 粉体塗装 (ブラック) 傘枠:スチ-ル 粉体塗装 (ブラック) 差込口: W65×D80mm×45個 受皿:樹脂成型品 (ブラック) 入数:1 ●45本収納 受皿枚数:(大) 3枚 ●受皿 (大) (小) のみの注文も対応致します。詳細はお問合わせ下さい。

KVO102(SV)+K-102T
傘立てオプションカバー 価格(税抜)サイズ(mm)梱包才数梱包重量
KVO92 18,200円 W917×D110×H4852.1才7.6kg
KVO102 20,500円 W1357×D110×H4853.0才8.6kg
仕様/本体:スチ-ル メラミン焼付塗装 入数:1 ●KVO92(SV):K-92S、KS-92S、K-92Tに対応・
●KVO102(SV):KS-102、K-102S、K-102Tに対応
K-27T K-48T
276
レンタル・リース
ステンレス 傘立て
チェアデスク・収納パーティションテーブルレセプションロビーエクステリアアクセサリー木工

傘立て 価格(税抜)サイズ(mm)梱包才数梱包重量
KS-27S 49,000円 W270×D300×H5000.5才3kg 仕様/本体:ステンレス (〼22mm) ヘアライン仕上げ 傘枠:ステンレス 差込口:W65× D80mm×9個 受皿:樹脂成型品 (ブラック) 入数:1 ●9本収納 受皿枚数:(小) 1枚 ● 受皿 (大) (小) のみの注文も対応致します。詳細はお問合わせ下さい。

傘立て 価格(税抜)サイズ(mm)梱包才数梱包重量 KS-48S 56,200円 W485×D300×H5000.6才4kg 仕様/本体:ステンレス (〼22mm) ヘアライン仕上げ 傘枠:ステンレス 差込口:W80× D80mm×15個 受皿:樹脂成型品 (ブラック) 入数:1 ●15本収納 受皿枚数:(大) 1枚 ●受皿 (大) (小) のみの注文も対応致します。詳細はお問合わせ下さい。



傘立て 価格(税抜)サイズ(mm)梱包才数梱包重量
KS-92S 68,000円 W920×D300×H5000.9才 5kg
KS-102S 91,000円 W1360×D300×H5001.5才 7.1kg
仕様/本体:ステンレス (〼22mm) ヘアライン仕上げ 傘枠:ステンレス 差込口:KS-92S/W80×D80mm×30個、 KS-102S/W65×D80mm×45個 受皿:樹脂成型品 (ブラック) 入数:1 ●KS-92S:30本収納、KS-102S:45本 収納 ●受皿枚数:KS-92S (大)2枚、KS-102S(大)3枚 ●受皿 (大) (小) のみの注文も対応致します。詳細は お問合わせ下さい。
スチール(本体)/ステンレス(傘枠)傘立て




幼保レンタル・リース
傘立て 価格(税抜)サイズ(mm)梱包才数梱包重量
K-27S 21,600円 W270×D300×H5000.5才3kg
K-48S 26,000円 W485×D300×H5000.6才4kg
仕様/本体:スチ-ル (〼22mm) 粉体塗装 (ブラック) 傘枠:ステンレス 差込口:W65×D80mm×9個・ 差込口:W80×D80mm×15個 受皿:樹脂成型品 (ブラック) 入数:1 ●K-27S:9本収納、K-48S:15 本収納 ●受皿枚数:K-27S (小)1枚、K-48S(大)1枚 ●受皿 (大) (小) のみの注文も対応致します。詳細 はお問合わせ下さい。
傘立て 価格(税抜)サイズ(mm)梱包才数梱包重量 K-92S 34,600円 W920×D300×H5000.9才5kg
K-102S 43,200円 W1360×D300×H5001.5才7.1kg 仕様/本体:スチ-ル (〼22mm) 粉体塗装 (ブラック) 傘枠:ステンレス 差込口:W80×D80mm×30個・ 差込口:W65×D80mm×45個 受皿:樹脂成型品 (ブラック) 入数:1 ●K-92S:30本収納、K-102S: 45本収納 ●受皿枚数:K-92S (大)2枚、K-102S(大)3枚 ●受皿 (大) (小) のみの注文も対応致します。 詳細はお問合わせ下さい。
KS-92S
KS-27S
KS-48S
KS-92S
K-27S
K-48S
K-92S
K-102S
277 SOCIA
KS-102S
折りたたみ式傘立て

折畳み式傘立て 価格(税抜)サイズ(mm)梱包才数梱包重量
K-F48T 18,900円 W460×D300×H5004.9才15kg
仕様/本体:スチ-ル 角パイプ (25×12mm) 粉体塗装 (ブラック) 傘枠:スチ-ル 粉体塗装 (ブラック) 差込 口:W80×D90mm×15個 受皿:樹脂成型品 (ブラック) 入数:4 折畳時:W460×D73×H770 ●15本収納 受皿枚数:(大) 1枚 ●受皿 (大) (小) のみの注文も対応致します。詳細はお問合わせ下さい。

折畳み式傘立て
価格(税抜)サイズ(mm)梱包才数梱包重量
K-F57A 30,400円 W570×D345×H5601.4才4kg 仕様/本体:アルミ (〼22mm) アルマイト仕上げ 傘枠:アルミ アルマイト仕上げ 差込口:W85×D110mm× 12個 受皿:樹脂成型品 (ブラック) 入数:1 折畳時:W570×D80×H880 ●12本収納 ※受皿の交換 はできません。

折畳み式傘立て 価格(税抜)サイズ(mm)梱包才数梱包重量 K-F92T 27,000円 W895×D300×H5005.1才13kg 仕様/本体:スチ-ル 角パイプ (25×12mm) 粉体塗装 (ブラック) 傘枠:スチ-ル 粉体塗装 (ブラック) 差 込口:W80×D90mm×30個 受皿:樹脂成型品 (ブラック) 入数:2 折畳時:W895×D73×H770 ●30本収納 受皿枚数:(大) 2枚 ●受皿 (大) (小) のみの注文も対応致します。詳細はお問合わせ下さい。

折畳み式傘立て 価格(税抜)サイズ(mm)梱包才数梱包重量 K-F81A 35,600円 W810×D345×H5602.0才5kg
仕様/本体:アルミ (〼22mm) アルマイト仕上げ 傘枠:アルミ アルマイト仕上げ 差込口:W85×D110mm× 18個 受皿:樹脂成型品 (ブラック) 入数:1 折畳時:W810×D80×H880 ●18本収納 ※受皿の交換 はできません。



アンブレラスタンド 価格(税抜)サイズ(mm)梱包才数梱包重量
BUS-25 20,000円 φ180×H4500.8才 2kg
BUS-26 26,000円 φ225×H4501.0才 2.2kg


傘袋 価格(税抜)
KAS-B 37,000円 仕様/材質:ポリエチレン 入数:2400
傘袋スタンド 価格(税抜)サイズ(mm)梱包才数梱包重量 KAS-1 141,000円 W275×D365×H7953.5才11kg 仕様/本体:スチ-ル (φ22.2mm) 粉体塗装 (グレ-) カバ-:樹脂成型品 (グレ-) 側板:スチ-ル 粉体塗 装 (グレ-) 入数:1 ●袋付 (1200枚)
かさっぱふくろト-ル 価格(税抜)サイズ(mm)梱包才数梱包重量 KAS-2 128,000円 W426×D365×H9774.8才11.4kg 仕様/本体:スチ-ルパイプ 粉体塗装 (シルバ-) ベ-ス投入口:スチ-ル 粉体塗装 (シルバ-) 側板:スチ -ル 粉体塗装 (ダ-クグレ-) スポンジ:EVA&CR発泡体 (二層貼) 入数:1 ●差し込むだけの簡単操作 で手を濡らさずに傘袋を取り外せます。 ●ヘッドを外せば屑入れとしてもご使用頂けます。
仕様/本体:ステンレス 受皿:樹脂成型品 入数:1
K-F48T
K-F92T
K-F57A
K-F81A
BUS-25
BUS-26
KAS-2
KAS-1
傘袋KAS-B 1200枚×2セット
278
アルミ製傘立て サビに強く、耐久性に優れた傘立てです。
チェアデスク・収納パーティションテーブルレセプションロビーエクステリアアクセサリー木工


傘立て 価格(税抜)サイズ(mm)梱包才数梱包重量
AS-9 29,000円 W300×D300×H5002.0才3kg
AS-18 37,000円 W560×D300×H5003.6才4kg
AS-27 46,000円 W820×D300×H5005.2才5kg
仕様/フレ-ム:アルミ 傘枠:樹脂成型品 (グレ-) 受皿:樹脂成型品 (ブラック) 入数:1 ●AS-9(差込 ロ:W75×D75mm×9個)、AS-18 (差込ロ:W75×D75mm×18個)、AS-27 (差込ロ:W75×D75mm×27個)


アルミパネル式 傘立て 価格(税抜)サイズ(mm)梱包才数梱包重量
AS-P9 48,000円 W300×D300×H5002.0才4.8kg
AS-P18 62,000円 W560×D300×H5003.6才6.8kg
AS-P27 76,000円 W820×D300×H5005.2才8.7kg
仕様/フレ-ム:アルミ 傘枠:樹脂成型品 (グレ-) 入数:1 ●AS-P9(差込ロ:W75×D75mm×9個)、 AS-P18 (差込ロ:W75×D75mm×18個)、AS-P27 (差込ロ:W75×D75mm×27個)
消毒液スタンド







背面下部から受皿を取り外せて 清掃等に便利です ・対応品番 AS-P9、P18、P27

消毒液のサイズによってトレーの位置を変更できます。

幼保レンタル・リース
ペダル式消毒液スタンド (シングルタイプ)
価格(税抜)サイズ(mm)梱包才数梱包重量 FPS-90 78,000円 W300×D345×H9875.0才8.5kg 仕様/支柱:アルミ押出成型品 アルマイト仕上げ 脚:スチ-ル 粉体塗装 (ホワイト) 入数:1 ●対応ボトル サイズ:丸ボトル/φ100mm以下、角ボトル/100×100mm以下 高さ60mm以上 ●消毒液受皿付属 ●工具 不要でボトル交換可能 ●プッシュ量調節可能
ペダル式消毒液スタンド (ダブルタイプ) 価格(税抜)サイズ(mm)梱包才数梱包重量
FPS-100 166,000円 W440×D400×H9877.8才13.6kg 仕様/支柱:アルミ押出成型品 アルマイト仕上げ 脚:スチ-ル 粉体塗装 (ホワイト) 入数:1 ●対応ボトル サイズ:丸ボトル/φ100mm以下、角ボトル/100×100mm以下 高さ60mm以上 ●消毒液受皿付属 ●工具 不要でボトル交換可能 ●プッシュ量調節可能 ●高さ調節可能 (3段階)
AS-9
AS-18
AS-27
AS-P9
AS-P18
AS-P27
FPS-90 FPS-100
279 SOCIA
案内板

BK BA



両面掲示板 (片面ピンサスボード、片面ホワイトボード) として使用頂けます。
掲示ボード 価格(税抜)サイズ(mm)梱包才数梱包重量
BK-416 88,000円 W415×D400×H14001.3才8kg
BK-666 99,000円 W685×D400×H14002.0才10kg
仕様/ボ-ド:(表面) 塩ビシ-ト貼り (裏面) ホワイトボ-ド フレ-ム:スチ-ル メラミン焼付塗装 (ダ-クグレ-) 入数:1 ●BK-416ボード内寸:W310×H860・●BK-666ボード内寸:W560×H860 ●指示ボ-ド面はピン・ マグネットが使用可能です。 ●ホワイトボ-ド面はマ-カ-・マグネットが使用可能です。
KAN



KAN-035(WH)(発泡レザー面)KAN-065(BK)(ホワイトボード面)
サインスタンド
NRSS



板背面のツマミを緩めれば 自由に角度を調節することができます。
サインスタンド 価格(税抜)サイズ(mm)梱包才数梱包重量
NRSS-450(BK) 84,000円 W460×D380×H10502.7才8.2kg
仕様/本体:スチ-ル サテン塗装 (ブラック) ボ-ド:アクリル (透明+ホワイト) 入数:1 ●パネル表示サイズ: W450×H440 ●角度調節が可能

案内板 価格(税抜)サイズ(mm)梱包才数梱包重量
BA-302 38,000円 W300×D400×H12500.7才5kg
BA-482 43,000円 W480×D400×H12501.0才7kg 仕様/ボ-ド部:スチ-ル (ホワイト) フレ-ム:スチ-ル 楕円パイプ (30×15mm) 粉体塗装 (ダ-クグレ-) 入数:1 ●BA-302ボード寸法:W250×H880・●BA-482ボード寸法:W430×H880 ●両面でマ-カ-・マ グネットが使用可能です。
両面掲示板片面(レザータイプ、片面ホワイトボード)として使用頂けます。
案内板 価格(税抜)サイズ(mm)梱包才数梱包重量
KAN-035 86,000円 W350×D400×H14001.6才9kg
KAN-050 94,000円 W495×D400×H14001.7才10kg
KAN-065 107,000円 W645×D400×H14002.2才11kg
仕様/ボ-ド部 (片面):スチ-ル (ホワイト) ボ-ド部 (片面):発泡レザ- フレ-ム:アルミ押出材 キャスタ-: φ50mm双輪ナイロンキャスタ- (ストッパ-付2個、ストッパ-無2個) 入数:1 ●KAN-035板面:W280× H878・●KAN-050板面:W425×H878・●KAN-065板面:W575×H878 ●マ-カ- (赤・黒各1色)・イレ イザ- (1個) 付 ●下枠が収納ポケットになっており、マ-カ-・イレイザ-等の収納が可能です。 ●レザ-面 はピンが使用可能です。ホワイトボ-ド面はマ-カ-・マグネットが使用可能です。


サインスタンド 価格(税抜)サイズ(mm)梱包才数梱包重量
NRSS-450(SV) 84,000円 W460×D380×H10502.7才8.2kg 仕様/本体:スチ-ル (シルバ-) ボ-ド:アクリル (透明+ホワイト) 入数:1 ●パネル表示サイズ:W450× H440 ●角度調節が可能
BK-666(表面)
BA-302
BK-666(裏面) ホワイトボード
NRSS-450(BK)
NRSS-450(SV) 背面 背面
280
サインスタンド
SSW
チェアデスク・収納パーティションテーブルレセプションロビーエクステリアアクセサリー木工



サインスタンド 価格(税抜) サイズ(mm)梱包才数梱包重量
SSW-A4 30,000円 W330×D330×H895~13350.6才4.4kg 仕様/表示枠:スチール(ホワイトグレー)、ボード:透明PET・ボール紙 支柱:スチ-ル (φ19.1mm) 塗装 (ホワ イトグレ-) ベ-ス:スチ-ル 塗装 (ホワイトグレ-) 入数:1 ●A4 (ヨコ) サイズに対応 ●両面タイプ
サインスタンド 価格(税抜) サイズ(mm)梱包才数梱包重量
SSW-B4 33,000円 W367×D330×H945~13850.6才4.7kg 仕様/表示枠:スチール(ホワイトグレー)、ボード:透明PET・ボール紙 支柱:スチ-ル (φ19.1mm) 塗装 (ホワ イトグレ-) ベ-ス:スチ-ル 塗装 (ホワイトグレ-) 入数:1 ●B4 (ヨコ) サイズに対応 ●両面タイプ
KSW




表示内容を、プレートとプレー トの間に差し込み使用します。
プレートには蓋があり、異物の 侵入を防ぎます。
サインスタンド 価格(税抜) サイズ(mm)梱包才数梱包重量
SSW-A3 38,000円 W423×D330×H985~14250.6才5.1kg 仕様/表示枠:スチール(ホワイトグレー)、ボード:透明PET・ボール紙 支柱:スチ-ル (φ19.1mm) 塗装 (ホワ イトグレ-) ベ-ス:スチ-ル 塗装 (ホワイトグレ-) 入数:1 ●A3 (ヨコ) サイズに対応 ●両面タイプ

サインスタンド 価格(税抜) サイズ(mm)梱包才数梱包重量 KSW-A4 33,000円 W330×D330×H860~13000.8才4.3kg 仕様/表示枠:スチール(ホワイトグレー)、ボード:透明PET・ボール紙 支柱:スチ-ル (φ19.1mm) 塗装 (ホワ イトグレ-) ベ-ス:スチ-ル 塗装 (ホワイトグレ-) 入数:1 ●A4 (ヨコ) サイズに対応 ●片面タイプ ● サインボ-ド部角度調節可能
サインスタンド 価格(税抜) サイズ(mm)梱包才数梱包重量
KSW-B4 36,000円 W367×D330×H910~13500.8才4.6kg 仕様/表示枠:スチール(ホワイトグレー)、ボード:透明PET・ボール紙 支柱:スチ-ル (φ19.1mm) 塗装 (ホワ イトグレ-) ベ-ス:スチ-ル 塗装 (ホワイトグレ-) 入数:1 ●B4 (ヨコ) サイズに対応 ●片面タイプ ● サインボ-ド部角度調節可能

表示内容を、プレートとプレー トの間に差し込み使用します。


プレートには蓋があり、異物の 侵入を防ぎます。

板背面のツマミを緩めれば自 由に角度を調節することができ ます。
サインスタンド 価格(税抜) サイズ(mm)梱包才数梱包重量 KSW-A3 41,000円 W423×D330×H950~13900.9才5kg
仕様/表示枠:スチール(ホワイトグレー)、ボード:透明PET・ボール紙 支柱:スチ-ル (φ19.1mm) 塗装 (ホワ イトグレ-) ベ-ス:スチ-ル 塗装 (ホワイトグレ-) 入数:1 ●A3 (ヨコ) サイズに対応 ●片面タイプ ● サインボ-ド部角度調節可能
幼保レンタル・リース
SSW-A4
SSW-B4
SSW-A3
KSW-A4
KSW-B4
KSW-A3
281 SOCIA
パンフレットスタンド

NKBP-C204

NKBP-C204(WH)
NSP

サイン&パンフレット スタンド (A4)

ボード
ホワイトボードとしても利用可能です。

マグネット 板面にポスターやチラシを貼り付ける際、 マグネットの使用が可能です。

パンフレットケース
最大4種のパンフレットやチラシを入れること が可能です。
掲示ボード付 パンフレットスタンド 価格(税抜) サイズ(mm) 梱包才数梱包重量
NKBP-C204 82,900円 W550×D360×H1590mm4.3才 15kg 仕様/本体:スチール角パイプ(粉体塗装) ワイヤー:スチール棒(粉体塗装) ボード:ホワイトボード(アルミ枠付) キャスター:Φ40mm キャスター(ストッパー付2個、ストッパー無2個) ケース:PS樹脂 入数:1 ●掲示ボード外寸法:W550×H760mm ●掲示ボード有効 寸法:W528×H738mm(B2サイズ515×728mm可能) ●ケース(ホワイト)4個付

価格(税抜)サイズ(mm)梱包才数梱包重量 NSP-102C 65,000円 W330×D330×H12642.6才8.8kg 仕様/本体・ベ-ス:スチ-ル 粉体塗装 (シルバ-) ケ-ス:樹脂成型品 (ホワイト/透明) 入数:1 ●付属チェ ンジパ-ツ:1個付 ●回転・両側仕様ではございません。
NDP


サイン&パンフレット スタンド (A3) 価格(税抜)サイズ(mm)梱包才数梱包重量 NSP-C202 93,000円 W532×D400×H13556.0才13kg 仕様/本体・ベ-ス:スチ-ル 粉体塗装 (シルバ-) ケ-ス:樹脂成型品 (ホワイト/透明) キャスタ-(ストッパ- 付2個、ストッパ-無2個) 入数:1 ●付属チェンジパ-ツ:1個付 ●上部のみA3サイズが入れれます。 (片 面のみ)



パンフレットスタンド 価格(税抜)サイズ(mm)梱包才数梱包重量
NDP-110 38,000円 W320×D460×H14502.7才7.8kg
NDP-210 55,000円 W473×D460×H14503.9才11kg
NDP-310 70,000円 W698×D460×H14504.3才14.2kg 仕様/本体:スチ-ル 粉体塗装 (シルバ-) 看板:ポリプロピレン 入数:1 ●NDP-10看板内寸:W225× H110、NDP-210看板内寸:W448×H110、NDP-310看板内寸:W673×H110 ●ワイヤ-有効寸法:D16 ●ワイヤ-部分が、湾曲してるのでチラシが倒れにくい構造になっています。 ●看板に名入れすることもできます。 (別途見積)
NSP-102C
NSP-C202
湾曲脚
NDP-310
NDP-210
ホルダーが湾曲しているので 冊子が折れない仕様になっています。
NDP-110
282
パンフレットスタンド
KSL
チェアデスク・収納パーティションテーブルレセプションロビーエクステリアアクセサリー木工


KP

NPF

①DM・A6
②A5・B5・B6



パンフレットスタンド 価格(税抜)サイズ(mm) 梱包才数梱包重量
KSL-C206 105,000円 W539×D465×H12208.1才 20.6kg
KSL-C306 129,000円 W783×D465×H122010.5才 27.3kg
KSL-C406 150,000円 W1035×D465×H122010.4才 35.5kg
仕様/フレ-ム:スチ-ル 角パイプ 粉体塗装 (シルバ-メタリック) ケ-ス:樹脂成型品 (グレ-/透明) 入数:1(2個口)
●付属チェンジパーツ:KSL-C206 2個付、KSL-C306 3個付、KSL-C406 4個付


パンフレットスタンド 価格(税抜)サイズ(mm)梱包才数梱包重量
KP-C105 50,000円 W308×D420×H15002.5才 9.8kg
KP-C205 75,000円 W551×D420×H15404.7才 16kg
KP-C305 100,000円 W794×D420×H15406.9才 21.6kg 仕様/フレ-ム:スチ-ル 楕円パイプ 粉体塗装 (シルバ-メタリック) ケ-ス:樹脂成型品 (グレ-/透明) 上部看板:樹 脂成型品 (ブラック) 入数:1(2個口) ●付属チェンジパーツ:KP-C105 1個付、KP-C205 2個付、KP-C305 3個付
●アジャスター仕様:KP-C105 ●キャスター仕様:KP-C205、KP-C305


使用例(DM・A5)
付属のチェンジパーツを使えば、さまざまなサイズのパンフレットを 入れることが可能です。①DM・A6サイズを入れる場合、仕切りの 向きを上にセット。②A5・B5・B6サイズを入れる場合は、仕切りの 向きを下にセット ※通常はA4サイズに対応
幼保レンタル・リース

パンフレットスタンド 価格(税抜)サイズ(mm)梱包才数梱包重量
NPF-C108 53,000円 W308×D420×H15002.8才 12kg
NPF-C208 81,000円 W551×D420×H15404.8才 20kg
NPF-C308 109,000円 W794×D420×H15406.9才 27kg
仕様/フレ-ム:スチ-ル 楕円パイプ 粉体塗装 (シルバ-メタリック) ケ-ス:樹脂成型品 (グレ-/透明) 上部看板:樹
脂成型品 (ブラック) 入数:1 ●付属チェンジパーツ:NPF-C108
2個付、NPF-C208 4個付、NPCF-C308 6個付 ●アジャスター仕様:NPF-C108 ●キャスター仕様:NPF-C208、NPF-C308
KSL-C206
KSL-C306
KSL-C406
文字入れ例
KP-C105
KP-C205
KP-C305
NPF-C108
NPF-C208
NPF-C308
283 SOCIA
パンフレットスタンド



AS-PF10(WH)AS-PF10(BK)



AS-PF20(WH) AS-PF20(BK) AS-PF30(WH)
パンフレットスタンド (直立型) 価格(税抜)サイズ(mm)梱包才数梱包重量
AS-PF10(BK/WH) 99,000円 W310×D455×H15552.6才12kg 仕様/フレーム:アルミ アルマイト仕上げ(艶なしブラック/艶ありホワイト) カセット:樹脂成型品 (BK:クリアブラック/ WH:クリア) キャスタ-:φ50mm双輪ナイロン (ストッパ-付4個) 入数:1(2個口) ●A4サイズ対応カセット:10個付
パンフレットスタンド (直立型) 価格(税抜)サイズ(mm)梱包才数梱包重量
AS-PF20(BK/WH) 133,000円 W545×D455×H15554.6才17kg
仕様/フレーム:アルミ アルマイト仕上げ(艶なしブラック/艶ありホワイト) カセット:樹脂成型品 (BK:クリアブラック/ WH:クリア) キャスタ-:φ50mm双輪ナイロン (ストッパ-付4個) 入数:1(3個口) ●A4サイズ対応カセット:20個付


AS-PF30(BK)
パンフレットスタンド (直立型) 価格(税抜)サイズ(mm)梱包才数梱包重量 AS-PF30(BK/WH) 169,000円 W775×D455×H15556.6才23kg 仕様/フレーム:アルミ アルマイト仕上げ(艶なしブラック/艶ありホワイト) カセット:樹脂成型品 (BK:クリアブラック/ WH:クリア) キャスタ-:φ50mm双輪ナイロン (ストッパ-付4個) 入数:1(4個口) ●A4サイズ対応カセット:30個付

パンフレットスタンド (直立型) 価格(税抜)サイズ(mm)梱包才数梱包重量
AS-PF10 89,000円 W310×D455×H15552.6才12kg 仕様/フレ-ム:アルミ アルマイト仕上げ カセット:樹脂成型品 (クリアブル-) 入数:1(2個口) ●A4サイズ対応カセット:10個付
パンフレットスタンド (直立型) 価格(税抜)サイズ(mm)梱包才数梱包重量
AS-PF20 121,000円 W545×D455×H15554.6才17kg 仕様/フレ-ム:アルミ アルマイト仕上げ カセット:樹脂成型品 (クリアブル-) 入数:1(3個口)
●A4サイズ対応カセット:20個付

パンフレットスタンド (直立型) 価格(税抜)サイズ(mm)梱包才数梱包重量 AS-PF30 155,000円 W775×D455×H15556.6才23kg 仕様/フレ-ム:アルミ アルマイト仕上げ カセット:樹脂成型品 (クリアブル-) 入数:1(4個口) ●A4サイズ対応カセット:30個付
AS-PF10
AS-PF20
AS-PF30
284
AS-PF20(BK)
AS-PF
チェアデスク・収納パーティションテーブルレセプションロビーエクステリアアクセサリー木工

AS-PF8N

AS-PF12N

AS-PF16N
パンフレットスタンド (傾斜型) 価格(税抜)サイズ(mm)梱包才数梱包重量
AS-PF8N 98,000円 W545×D490×H12552.8才12kg
仕様/フレ-ム:アルミ アルマイト仕上げ カセット:樹脂成型品 (クリアブル-) 入数:1(3個口) ●A4サイズ対応カセット:8個付
パンフレットスタンド (傾斜型) 価格(税抜)サイズ(mm)梱包才数梱包重量
AS-PF12N 119,000円 W775×D490×H12553.2才15kg
仕様/フレ-ム:アルミ アルマイト仕上げ カセット:樹脂成型品 (クリアブル-) 入数:1(4個口)
●A4サイズ対応カセット:12個付
マガジンスタンド
KNM


マガジンスタンド 価格(税抜)サイズ(mm)梱包才数梱包重量
KNM-330 68,000円 W700×D390×H9502.3才 12kg
KNM-340 80,000円 W700×D480×H11003.4才 15.5kg
KNM-350 88,000円 W700×D580×H12504.5才 18kg 仕様/本体:スチ-ル 粉体塗装 (シルバ-) ラック:スチ-ル 粉体塗装 (シルバ-) 入数:1 ●ラック内寸:W656×D54×H320 ●キャスタ-:ストッパ-付2個、ストッパ-無2個

マガジンスタンド (フロアタイプ) 価格(税抜)サイズ(mm)梱包才数梱包重量
NFM-50(GM) 49,000円 W510×D480×H4001.4才7.6kg
仕様/本体:スチ-ル ガンメタリック焼付塗装 入数:1
●ラック内寸:(前) W470×D70×H280 ●ラック内寸:(中・後) W470×D61×H280
パンフレットスタンド (傾斜型) 価格(税抜)サイズ(mm)梱包才数梱包重量
AS-PF16N 139,000円 W1010×D490×H12554.7才18kg
仕様/フレ-ム:アルミ アルマイト仕上げ カセット:樹脂成型品 (クリアブル-) 入数:1(5個口)
●A4サイズ対応カセット:16個付


幼保レンタル・リース
マガジンスタンド (フロアタイプ) 価格(税抜)サイズ(mm)梱包才数梱包重量
NFM-50(SV) 49,000円 W510×D480×H4001.4才7.6kg
仕様/本体:スチ-ル 粉体塗装 (シルバ-) 入数:1
●ラック内寸:(前) W470×D70×H280 ●ラック内寸:(中・後) W470×D61×H280
KNM-330
KNM-340
KNM-350
NFM-50(GM)
NFM-50(SV)
285 SOCIA
木製マガジンスタンド


PAN

マガジンスタンド 価格(税抜)サイズ(mm)梱包才数梱包重量
PAN-11 29,000円 W600×D400×H12601.8才17kg
仕様/本体:フラッシュ加工 プリント紙化粧板貼り 入数:1
●棚内寸 (上4段):W566×D45 下棚:W566×D300×H330

マガジンスタンド 価格(税抜)サイズ(mm)梱包才数梱包重量
PAN-12 36,000円 W900×D400×H12602.9才21kg
仕様/本体:フラッシュ加工 プリント紙化粧板貼り 入数:1
●棚内寸 (上4段):W866×D45 下棚:W866×D300×H330
PLK



マガジンラック 価格(税抜)サイズ(mm)梱包才数梱包重量
PLK-11 28,000円 W600×D345×H8001.5才13kg
仕様/本体:フラッシュ加工 プリント紙化粧板貼り 入数:1
●棚内寸 (上2段):W566×D72 下段:W566×D68 下棚:W566×D283×H250 ●ディスプレイ桟付
PAN-11
G-B
PLK-11
PAN-11
PAN-12
使用例
PLK-11
286
ベルトパーティション
チェアデスク・収納パーティションテーブルレセプションロビーエクステリアアクセサリー木工

BP


ベルトパーティション 価格(税抜)サイズ(mm)梱包才数梱包重量
BP-3586ST 71,000円 φ350×H8553.0才 9kg 仕様/支柱:ステンレス (φ60.5mm) ミラ-仕上げ ベ-ス:ステンレス (φ350mm) ヘアライン仕上げ 入数:2 ●ベルト長:2000mm ●スタッキング可能
オプションパーツ


三方向キャッチ 価格(税抜)
BP-3C 16,000円
仕様/本体:樹脂成型品 (ダ-クグレ-) 入数:1 ●既存のベルトパ-ティション のキャッチ部に装着するだけで3方向キャッチになります。 ●BP-3586STに対応
■ベルトカラーサンプル(BP-3586ST)








サインホルダー 価格(税抜)
BP-SH 23,000円
仕様/本体:アクリル ホルダ-:樹脂成型品 (ダ-クグレ-) 入数:1 ●ベルトパ-ティションのヘッド部に装着するだけでB5サイズのサインスタンドになります。 ●透明アクリル板に挟んだ用紙を交換することでサインを自由に差し替えることが可能です。 ●BP-3586STに対応。
BP-3586ST(BK)
スタッキング例
BP-3C ダークグレー
BP-SH ブラック 三方向キャッチ装着例
ブラウン ブラック グレー グリーン イエロー ブルー レッド
287 SOCIA
BP-3586ST(レッド)
幼保レンタル・リース
記載台

NUK-480(WH)

受付 記載台 価格(税抜)サイズ(mm)梱包才数梱包重量 NUK-480 63,000円 W480×D375×H9202.6才11.1kg 仕様/本体:スチ-ル (サテンホワイト焼付塗装) フレ-ム:スチ-ル 粉体塗装 (シルバ-) 入数:1 天板サイズ:W480×D370 棚有効寸法:W415×D230×H50 (155) ●全体平均分布荷重約20kg、 天板15kg、棚5kg

NUK-480(WH)+NUK-B(WH)+ NOPC(WH)

NUK/NIF用 パンフレットケース 価格(税抜)サイズ(mm)梱包才数梱包重量
NOPC(GR/WH) 8,000円 W235×D40×H3300.3才0.8kg 仕様/パンフレットケ-ス:PS樹脂 (グレー/ホワイト) 入数:1
受付 記載台用掲示 ボード 価格(税抜)サイズ(mm)梱包才数梱包重量 NUK-B 16,000円 W445×D15×H3800.4才1.9kg 仕様/フレ-ム:スチ-ル 粉体塗装 (シルバ-) パネル:スチ-ル (サテンホワイト焼付塗装) 入数:1

KK-120H
KK-90H

記載台ハイタイプ 価格(税抜)サイズ(mm)梱包才数梱包重量
123,000円 W1200×D450×H9505.5才27kg
106,000円 W900×D450×H9504.6才22kg
仕様/本体:スチ-ル 粉体塗装 天板:低圧メラミン化粧板 (t25mm) ロ-カンエッジ 入数:1 ●アジャスタ-付
卓上パンフレットスタンド
NPC KK





KK-90H+KK-P90+KK-OP
※卓上ケース別売り
記載台用掲示ボード 価格(税抜)サイズ(mm)梱包才数梱包重量
KK-P120 50,000円 W1140×D30×H4842.4才8.3kg
KK-P90 47,000円 W840×D30×H4841.8才6.8kg 仕様/本体:スチ-ル 楕円パイプ パネル:スチ-ル (パンチング) 入数:1 ●パンフレットケ-ス1個 (サイズ チェンジパ-ツ付) ●ペ-パ-ロック1本 (W210mm) 付 ●パネルはスチ-ル製なのでマグネットの使用が可 能。 ●後付け可能
記載台プライバシー パネル (2枚組) 価格(税抜)サイズ(mm)梱包才数梱包重量
KK-OP 74,000円 W450×D505×t140.6才5kg 仕様/本体:PVC乳白色 (半透明) 補強枠:スチ-ル 粉体塗装 (シルバ-) 入数:1 使用時のサイズ:W435×H450×t9 ●アクリル板はR180に加工してあります。

パンフレットケース (サイズチェンジパーツ付)

①DM・A6
②A5・B5・B6
付属のチェンジパーツを使えば、さまざま なサイズのパンフレットを入れることが可能 です。①DM・A6サイズを入れる場合、 仕切りの向きを上にセット。②A5・B5・ B6サイズを入れる場合は、仕切りの向き を下にセット ※通常はA4サイズに対応
卓上パンフレットスタ ンド 価格(税抜)サイズ(mm)梱包才数梱包重量
NPC-C101 9,000円 W235×D160×H315 0.2才1kg
NPC-C102 23,000円 W255×D190×H380 0.8才2.5kg
NPC-C202 32,000円 W490×D190×H380 1.6才4.3kg
仕様/フレ-ム:スチ-ル
粉体塗装 (シルバ-メタリック) ケ-ス:樹脂成型品 (グレ-/透明) 入数:1 ●付属チェンジパ-ツ:1個付・●付属チェンジパ-ツ:2個付・●付属チェンジパ-ツ:4個付
NUK
背面
KK-120H
KK-90H
KK-120H+KK-P120
NPC-C101
NPC-C102
NPC-C202
288
インフォメーションスタンド
NUM
チェアデスク・収納パーティションテーブルレセプションロビーエクステリアアクセサリー木工


受付台

新聞掛


モニター取付金具 オプションでモニター取付パーツ (角度調整4段階可) 使用例 ※モニターとモニター取付金具は付属 していません。

配線ホール 電子機器の配線を支柱内(コードホー ル)を通して収納可能。
受付・モニタースタンド 価格(税抜) サイズ(mm)梱包才数梱包重量
NUM-50 103,300円 W500×D460×H940mm3.7才12.6kg
仕様/天板・脚部:スチール粉体塗装 支柱:アルミ押出材・アルミ複合パネル キャスター:φ50㎜ナイロン 樹脂(ストッパー付2個、ストッパー無2個) 入数:1 ●背面に配線ホール2個付
モニター取付金具
価格(税抜)梱包才数梱包重量 NUM-MT(BK/WH) 17,100円 0.2才 1kg
仕様/モニター取付パーツ:スチールパイプ粉体塗装 入数:1 ●角度調整4段階可能
NR MUD


新聞掛 価格(税抜)サイズ(mm)梱包才数梱包重量
NR-1 55,000円 W650×D400×H8901.7才7kg
NR-2 39,000円 W650×D400×H7500.8才5kg
仕様/本体:スチ-ル 角パイプ (25×12mm) メラミン焼付塗装 入数:1 ●ペ-パ-ハンガ-5本付
●NR-1:収納部内寸W615×D40×H140


受付台 価格(税抜)サイズ(mm)梱包才数梱包重量
MUD-640 34,000円 W600×D400×H10003.2才18.5kg
仕様/天板:ポリ化粧板 (t31mm) フラッシュ加工 本体:プリント紙化粧板 (t31mm) フラッシュ加工 入数:1
●有効内寸:W533×D366×上部H377/下部H562mm

幼保レンタル・リース

つまみ部(断面図) 新聞紙100枚相当
ペーパーホルダー 価格(税抜)サイズ(mm)梱包才数梱包重量
PH-5 10,500円 W620×D42×H390.3才 1.4kg
仕様/本体:アルミ 入数:1 挟み込み内寸:W580×D11×H15 ●1セット=5本
背面
MUD-640
NUM-50(BK)
NUM-50(WH)
NR-2
NR-1
PH-5
289 SOCIA
ホワイトボード

WBS

マグネットが使用可能な両面ホワイトボード



裏面の木目柄の板面もホワイトボードと同じ ように使用することができます。
両面対応の粉受兼ペントレーが付属します。
ミーティングボード 価格(税抜) サイズ(mm)梱包才数梱包重量
WBC-9045B 54,300円 W900×D450×H1605mm 3.6才11kg
仕様/ボード:MDF フレーム:スチール 粉体塗装(ブラック) 入数:1 キャスター:ストッパー付き4個

スチール両面ホワイトボード 価格(税抜)サイズ(mm)梱包才数梱包重量 WBS-1209RF
45,000円 W1290×D525×H18103.6才16.4kg 仕様/●ボ-ド:スチ-ル フレ-ム:スチ-ル 粉体塗装 (ホワイト) 入数:1(2個口) ●ボ-ド:W1210× D19×H910 ●回転ストッパ-付 ●キャスタ-:ダブルロック機構付4個 ●粉受付 ●マ-カ- (赤・黒)・イ レイザ-付

粉受

マーカーとイレイザーが付属します。

ワンタッチストッパーを押すと、板面 が回転でき、また確実に固定しま す。
スチール両面ホワイトボード 価格(税抜)サイズ(mm)梱包才数梱包重量 WBS-1809RF 60,000円 W1890×D525×H1810 ▲ 5.2才21.2kg 仕様/ボ-ド:スチ-ル フレ-ム:スチ-ル 粉体塗装 (ホワイト) 入数:1(2個口) ●ボ-ド:W1810×D19 ×H910 ●回転ストッパ-付 ●キャスタ-:ダブルロック機構付4個 ●粉受付 ●マ-カ- (赤・黒)・イレイ ザ-付
WHP


ホーロー回転片面 ホワイトボード
WHP-912
WHP-918
WHP-1218

価格(税抜)サイズ(mm)梱包才数梱包重量
93,200円 W1280×D550×H18251.6才21.7kg
106,000円 W1880×D550×H1825 ▲ 2.3才29.5kg
168,000円 W1880×D550×H1975 ▲ 2.8才35.5kg
仕様/ボ-ド:ホ-ロ-ホワイト 脚フレ-ム:スチ-ル メラミン焼付塗装 キャスタ-:φ50mmゴムキャスタ- (ストッ パ-付2個、ストッパ-無2個) 入数:1(2個口) ●ボード:1218/W1800×D14×H1200・912/W1200× D14×H900・918/W1800×D14×H900 ●ネジ式回転ストッパ-付 ●粉受付 ●裏側 カラ-鉄板 ●マ-カ- (赤・黒)・イレイザ-・マグネット付

粉受付

ボードストッパー
ホーロー回転両面 ホワイトボード 価格(税抜)サイズ(mm)梱包才数梱包重量
WHP-R912 106,600円 W1280×D550×H18251.6才22.8kg
WHP-R918 115,500円 W1880×D550×H1825 ▲ 2.3才31kg
WHP-R1218 211,000円 W1880×D550×H1975 ▲ 2.8才36.5kg
仕様/ボ-ド:ホ-ロ-ホワイト 脚フレ-ム:スチ-ル メラミン焼付塗装 キャスタ-:φ50mmゴムキャスタ- (ストッ パ-付2個、ストッパ-無2個)
入数:1(2個口) ●ボード:1218/W1800×D14×H1200・912/W1200× D14×H900・918/W1800×D14×H900 ●ネジ式回転ストッパ-付 ●粉受付 ●マ-カ- (赤・黒) ・ イレイザ-・マグネット付
WBS-1209RF
WBS-1809RF
WHP-912
WHP-R918
WBC-9045B
WBC-9045B
290
KYB-B300
WUD

チェアデスク・収納パーティションテーブルレセプションロビーエクステリアアクセサリー木工



ミーティングボード 価格(税抜)サイズ(mm)梱包才数梱包重量
WUD-55B 137,000円 W1318×D557×H1750 ▲ 4.7才17.8kg 仕様/ボ-ド:(表面) ホ-ロ-ホワイト鋼板 (裏面) スチ-ルブラック鋼板 枠:アルミ押出型材 (黒アルマイト処理) ベ-ス:スチ-ル (メラミン焼付塗装) キャスタ-:φ50mm双輪ナイロンキャスタ- (ストッパ-付2個、ストッパ- 無2個) 入数:1 ●マ-カ- (赤・黒)・イレイザ-・マグネット2個付 ●裏面ブラックボ-ドには付属のマ-カ- とイレイザ-は使用できません。

POPゲルチョークを使った例 (POPゲルチョークは別売です)
オプション ゲルチョーク (8本) 価格(税抜)
WUD-GEL 5,000円
脱着式ペントレイ 価格(税抜)サイズ(mm)梱包才数梱包重量
WUD-PT 9,000円 W548×D42×H350.1才 0.4kg 仕様/本体:アルミ押出型材 (黒アルマイト処理) 裏面:マグネットシ-ト付 サイドカバ-:ABS樹脂成型品 入数:1 ●マグネット付で簡単に脱着が可能
TUD

粘着糊付マグネット

透明ボード 横型 価格(税抜)サイズ(mm)梱包才数梱包重量
TUD-36Y 265,000円 W1839×D557×H1750 ▲ 6.5才28.5kg 仕様/ボ-ド:透明アクリル (t5mm) (表面のみ:特殊コ-ティング加工) 枠:アルミ押出型材 (アルマイト処理) ベ-ス:スチ-ル メラミン焼付塗装 (シルバ-) キャスタ-:φ50mm双輪ナイロンキャスタ- (ストッパ-付2個、ス トッパ-無2個) 入数:1(2個口) ●グラスボ-ドマ-カ- (白・黒・蛍光ピンク・蛍光オレンジ・蛍光イエロ-・ ライトブル-)・専用イレイザ-・粘着糊付マグネット付
KMO

取っ手付


ミーティング用ボード (折畳み式) 価格(税抜)サイズ(mm)梱包才数梱包重量
KMO-800 89,600円 W604×D535×H16004.1才9kg
仕様/本体:スチ-ルパイプ/スチ-ル板 粉体塗装 板面:ホワイトボ-ド 入数:1 ●折畳時:W604×D85 ×H1110 ●ボ-ド寸法:W604×H886 ●使いやすい高さに調節できます。 (1010~1600mm) ●折り 畳み機構。 (指つめ防止のロック機構付) ●持ち運びに便利な取っ手付。



収納ボックス 開閉自在のラッチ機能で、マーカーやイ レイザーをきれいに収納できます。
※「TUD-36Y」には収納ボックスは付 きませんのでご注意ください。
透明ボード 横型 価格(税抜)サイズ(mm)梱包才数梱包重量 TUD-34Y 163,000円 W1229×D557×H1750 ▲ 4.8才18kg 仕様/ボ-ド:透明アクリル (t5mm) (表面のみ:特殊コ-ティング加工) 枠:アルミ押出型材 (アルマイト処理) ベ-ス:スチ-ル メラミン焼付塗装 (シルバ-) キャスタ-:φ50mm双輪ナイロンキャスタ- (ストッパ-付2個、ス トッパ-無2個) 入数:1 ●グラスボ-ドマ-カ- (白・黒・蛍光ピンク・蛍光オレンジ・蛍光イエロ-・ライトブル-) ・専用イレイザ-・粘着糊付マグネット付
KMB

幼保レンタル・リース
スタッキング

高さ調整可能 KMB-700

ミーティング用ボード 価格(税抜) サイズ(mm)梱包才数梱包重量
KMB-700 88,500円 W914×D382×H1385~16407.3才14kg
仕様/本体:楕円パイプ (15×30mm) 粉体塗装 ボ-ド:スチ-ル 塗装 (ホワイト) 入数:1 ●ボ-ド: W914×D914 ●キャスタ-:ストッパ-付2個、ストッパ-無2個 ●平行スタッキングピッチ:115mm ●ボ-ド: 縦横裏表使用可能 ●ボ-ド面脱着可能 ●板面:3段階 (粉受位置高さ:460,590,720mm) で高さ調節可 能
WUD-55B
WUD-PT(BK)
KMO-800
TUD-36Y
TUD-34Y
粘着糊付マグネット
291 SOCIA
高さ調整可能。
壁掛用ホワイトボード マーカータイプ

ホーロータイプ 価格(税抜)サイズ(mm)梱包才数梱包重量
WH-345 9,400円 W450×H3000.3才 2kg
WH-456 13,800円 W600×H4500.6才 3kg
WH-609 23,100円 W900×H6001.3才 6kg
WH-612 36,700円 W1200×H6001.7才 10kg
WH-912 37,500円 W1200×H9001.9才 12kg
WH-918 54,400円 W1800×H900 ▲ 2.8才18kg
仕様/無地 入数:1 ●吊金具付 ●粉受付 ●マ-カ- (赤・黒)・マグネット・イレイザ-付


スチールタイプ 価格(税抜)サイズ(mm)梱包才数梱包重量
WS-345 9,000円 W450×H3000.3才 2kg
WS-456 13,000円 W600×H4500.6才 3kg
WS-609 22,000円 W900×H6001.3才 6kg
WS-912 35,000円 W1200×H9001.9才 12kg
WS-918 49,000円 W1800×H900 ▲ 2.8才18kg
仕様/無地 入数:1 ●吊金具付 ●粉受付 ●マ-カ- (赤・黒)・マグネット・イレイザ-付
ファニチャータイプ (マグネット着磁型)


予定表 (無地) 価格(税抜)サイズ(mm)梱包才数梱包重量
FW-635 14,000円 W350×H6000.3才 1kg
FW-935 17,000円 W350×H9000.4才 2kg
FW-906 23,000円 W600×H9000.7才 3kg
仕様/ 入数:1 ●付属品:専用ポケット・マ-カ- (黒・赤×各1)・イレイザ- ●ホワイトボ-ド部:スチ-ルタ イプ
予定表 (行動予定) 価格(税抜)サイズ(mm)梱包才数梱包重量
FW-A635 15,000円 W350×H6000.3才 1kg 仕様/ 入数:1 ●付属品:専用ポケット・マ-カ- (黒・赤×各1)・イレイザ- ●ホワイトボ-ド部:スチ-ルタ イプ
月予定表 (壁掛用ホーローホワイト)



月予定表・タテ書2段 価格(税抜)サイズ(mm)梱包才数梱包重量
WH-M456 14,500円 W600×H4500.6才3kg
WH-M609 25,000円 W900×H6001.3才6kg
WH-M912 40,300円 W1200×H9001.9才12kg
仕様/ 入数:1 ●粉受付 ●イレイザ-・マ-カ- (赤・黒) 付・マグネット付属 ●吊金具付
月予定表・タテ書1段 価格(税抜)サイズ(mm)梱包才数梱包重量
WH-M918 57,000円 W1800×H900 ▲ 2.8才18kg
仕様/ 入数:1 ●粉受付 ●イレイザ-・マ-カ- (赤・黒) 付・マグネット付属 ●吊金具付



予定表 (週予定) 価格(税抜)サイズ(mm)梱包才数梱包重量
FW-W635 15,000円 W350×H6000.3才 1kg
仕様/ 入数:1 ●付属品:専用ポケット・マ-カ- (黒・赤×各1)・イレイザ- ●ホワイトボ-ド部:スチ-ルタ イプ
予定表 (月予定) 価格(税抜)サイズ(mm)梱包才数梱包重量 FW-M935 19,000円 W350×H9000.4才 2kg 仕様/ 入数:1 ●付属品:専用ポケット・マ-カ- (黒・赤×各1)・イレイザ- ●ホワイトボ-ド部:スチ-ルタ イプ




月予定表・ヨコ書2行 価格(税抜)サイズ(mm)梱包才数梱包重量
WH-M456Y 14,500円 W600×H4500.6才3kg
WH-M609Y 25,000円 W900×H6001.3才6kg
WH-M912Y 40,300円 W1200×H9001.9才12kg
WH-M918Y 57,000円 W1200×H900 ▲ 2.8才18kg
仕様/ 入数:1 ●粉受付 ●イレイザ-・マ-カ- (赤・黒) 付・マグネット付属 ●吊金具付
WS-345 WH-345
FW-635
FW-A635
FW-W635
FW-M935
■タテ書タイプ
■ヨコ書タイプ
WH-M918
WH-M912 WH-M456
WH-M918Y
WH-M912Y WH-M456Y
292
掲示板
■カラーサンプル(TKB)

木目柄掲示板
チェアデスク・収納パーティションテーブルレセプションロビーエクステリアアクセサリー木工














木目柄ホワイトボード (壁掛タイプ) 価格(税抜)サイズ(mm)梱包才数梱包重量
TWB-W609 39,000円 W910×D70×H6171.7才3kg
TWB-W912 55,000円 W1210×D70×H9173.4才5kg
TWB-W918 70,000円 W1810×D70×H917 ▲ 5.0才8kg
仕様/枠材:LVS 木目シ-ト貼り 入数:1 ●粉受付 ●吊金具付 ●ホワイトボ-ド部:スチ-ルタイプ ●ピンでの固定不可
壁掛用掲示板・屋内用案内掲示板

■カラーサンプル(PB・PMBタイプ)


IV:アイボリー
GN:グリーン



木目柄掲示板 (ピンマグ両用タイプ) 価格(税抜)サイズ(mm)梱包才数梱包重量
TKB-W609 32,300円 W900×H6000.6才 5kg
TKB-W912 49,900円 W1200×H9001.2才 9kg
TKB-W918 68,800円 W1800×H900 ▲ 1.9才12kg
仕様/枠材:MDF木目シ-ト貼り 入数:1 ●吊金具付 ●板面は11色の中からお選び頂けます。



LB:ライトブラウン
ピンタイプ 価格(税抜)サイズ(mm) 梱包才数梱包重量
PB-609 18,000円 W900×H600 0.6才4kg
PB-912 31,000円 W1200×H900 1.2才8kg
PB-918 50,000円 W1800×H900 ▲ 1.8才11kg 仕様/ビニ-ルレザ-貼り ボ-ド:ベニヤ 入数:1 ●吊金具付 ●マグネットは対応していません。
壁掛けボード



LM:ライトメジューム
マグネットタイプ 価格(税抜)サイズ(mm) 梱包才数梱包重量
PMB-609 22,000円 W900×H600 0.6才5kg
PMB-912 38,000円 W1200×H900 1.2才9kg
PMB-918 61,000円 W1800×H900 ▲ 1.8才12kg
仕様/ビニ-ルレザ-貼り ボ-ド:鉄箔+ベニヤ 入数:1
●吊金具付 ●PMBタイプは専用マグネット2個付 ●ピンでの固定不可


軽量ピンタイプ 価格(税抜)サイズ(mm)梱包才数梱包重量
PBK-609 19,000円 W905×H6050.8才 1.9kg
PBK-912 32,000円 W1205×H9051.5才 3.2kg
PBK-918 52,000円 W1805×H905 ▲ 2.2才4.4kg
仕様/ボ-ド:ポリプロピレン 発泡塩ビシ-ト貼り 枠フレ-ム:アルミ 入数:1 ●タテでもヨコでもお使いいた だけます。 ●吊金具は吊り上げ型・吊り下げ型の兼用タイプ ●ボ-ドは5色から選べます。 ●マグネットは対 応していません。


文字入れはオプションになります。
■カラーサンプル(PMS)


IV

LM ライトメジューム


ピン・マグ両用 タイプボード 価格(税抜)サイズ(mm) 梱包才数梱包重量
PMS-609 31,000円 W900×H600 0.5才4.8kg
PMS-912 47,000円 W1200×H900 1.0才8kg
PMS-918 63,000円 W1800×H900 ▲ 1.5才12kg 仕様/ボ-ド:インシュレ-ションボ-ド 発泡塩ビシ-ト貼り 枠フレ-ム: アルミ 入数:1 ●タイトル文字はオプションです。 ●上部・下部タイト ル 各H60×W860mm ●ボ-ドは5色から選べます。 ●PMSタイプは 専用マグネット2個付 ●吊金具付属




幼保レンタル・リース

ピンレスタイプ 価格(税抜)サイズ(mm)梱包才数梱包重量
TBY-609 27,700円 W905×H6050.8才 3.6kg
TBY-912 51,400円 W1205×H9051.5才 5.2kg
TBY-918 69,500円 W1805×H905 ▲ 2.2才6.7kg
仕様/ボ-ド:ポリスチレン発泡体 アルミ複合板 弱粘着加工紙 (コルク柄) 張りABS樹脂 枠フレ-ム:アルミ角部 入数:1 ●タテでもヨコでもお使いいただけます。 ●吊金具は吊り上げ型・吊り下げ型の兼用タイプ ●厚い 紙、重量のある紙、ざらついている紙は長時間の掲示で落下するおそれがあります。 ●化学処理してある紙は 接着しない場合があります。 ●新聞紙・わら半紙など、紙の種類によっては、取り外し時に紙間はく離を起こし、 掲示物が取れない恐れがあります。 ●油分は粘着力を低下させるので、表面を指で触れないで下さい。およそ 300回の脱着性能がありますが、設置環境によって変化します。 ●マグネットは対応していません。
TWB-W912
TKB-W609 (ソフトミントグリーン)
TKB-W918(ライトベージュ) 粉受け 吊り金具
PMB-609(ライトメジューム)
PMB-609(ライトブラウン)
PMS-609(グリーン)
PBK-918(IV)
PBK-912(GN)
TBY-918(コルク)
コルク
LM:ライトメジューム IV:アイボリー GN:グリーン
TBY-609(LGR)
LGR:ライトグレー
■カラーサンプル(PBK)
アイボリー コルク
GN グリーン LGR ライトグレー
ライトベージュ クールグレー ライトグレー グリーン パールピンク
アイボリー ライトブラウン オフホワイト
293 SOCIA
ライトメジューム
パウダーブルー ソフトミントグリーン
カウンターシリーズ

ハイカウンター(H1000㎜)
A4サイズ収納可能な棚付で棚下のスペースにも備品などが収納可能。 (H1000㎜)



ハイカウンター 価格(税抜)サイズ(mm)梱包才数梱包重量
HCT-1245 53,000円 W1200×D450×H1000 4.3才25.2kg
HCT-945 50,000円 W900×D450×H1000 3.2才20.6kg 仕様/天板:ポリエステル化粧板 フラッシュ加工 幕板:プリント紙化粧板貼り フラッシュ加工 側板:パ-ティ クルボ-ド プリント紙化粧板貼り 入数:1 ●有効内寸:1200サイズ:W1148×D397×上部:H350/下部: H600 900サイズ:W848×D397×上部:H350/下部:H600
ローカウンター(H700㎜)


ローカウンター 価格(税抜)サイズ(mm)梱包才数梱包重量
LCT-1460 54,000円 W1400×D600×H7003.3才20.2kg
LCT-760 41,000円 W700×D600×H7002.1才14kg
仕様/天板:ポリエステル化粧板 フラッシュ加工 本体:プリント紙化粧板貼り フラッシュ加工 入数:1 ●幕板は中央位置への組み付けになります。 ●脚間有効寸法:1400サイズ:W1348×H675 700サ イズ:W648×H675

ハイコーナーカウンター

ハイコーナーカウンター 価格(税抜)サイズ(mm)梱包才数梱包重量
HCT-C445 38,000円 W450×D450×H10001.7才10.5kg
仕様/天板:ポリエステル化粧板 フラッシュ加工 側板:パ-ティクルボ-ド プリント紙化粧板貼り 入数:1
ローコーナーカウンター(H700㎜)

ローコーナーカウンター 価格(税抜)サイズ(mm)梱包才数梱包重量 LCT-C600 37,000円 W600×D600×H7001.5才12.2kg
仕様/天板:ポリエステル化粧板 フラッシュ加工 本体:プリント紙化粧板貼り フラッシュ加工 入数:1
テーブル TA-1890B(NA) P.210
チェア
CK01(BK) P.079
HCT-1245
LCT-1460
HCT-945
HCT-C445
LCT-1460(WH) LCT-760(WH) LCT-C600(WH)
HCT-1245(WH)
HCT-945(WH)
HCT-1245 内側
HCT-C445(WH)
1200 1000 900 1000 1148/848 450 350 600 450 1000 600 1400 700 675 1348 600 700 700 648 675 600 700 294
ディスプレイスタンド
チェアデスク・収納パーティションテーブルレセプションロビーエクステリアアクセサリー木工


【使用例】

スタンド下部には配線を格納する スペースを内蔵しています。
ディスプレイスタンド 価格(税抜)サイズ(mm)梱包才数梱包重量
NDS-100 158,000円 W750×D750×H14604.4才30.5kg
仕様/本体:スチ-ル 粉体塗装 (ブラック/ホワイト) アルミ アルマイト仕上げ (ブラック/シルバー) 配線カバ-:
スチ-ル 粉体塗装 (ブラック/ホワイト) キャスタ-:エラストマ-樹脂 (φ75mm) (ストッパ-付2個、ストッパ-無 2個) 入数:1(2個口) ●対応ディスプレイサイズ:43~65インチ ●VESA規格 (TV後方のビス穴) 100× 100 ~400×400以下対応 (100単位) ●OAタップ等配線関係が収納可能


棚板 価格(税抜)サイズ(mm)梱包才数梱包重量
NDS-SF1 14,000円 W470×D345×H700.3才1.9kg
仕様/本体:スチ-ル 粉体塗装 (ブラック/ホワイト) 入数:1








木目フロントパネル 価格(税抜)サイズ(mm)梱包才数梱包重量
NDS-FP1(AK/NA) 8,000円 W240×t3×H9590.04才0.6kg
仕様/パネル:MDF プリント化粧板 入数:1


カメラスタンド 価格(税抜)サイズ(mm)梱包才数梱包重量
NDS-CS1 13,000円 W280×D82×H3900.4才0.9kg
仕様/本体:スチ-ル 粉体塗装 (ブラック/ホワイト) 入数:1

幼保レンタル・リース

リモコンラック 価格(税抜)サイズ(mm)梱包才数梱包重量
NDS-RR1
バックパネル 価格(税抜)サイズ(mm)梱包才数梱包重量
NDS-BP1 48,000円 W900×D76×H6503.0才6.5kg
仕様/本体:アルミ 粉体塗装 (ブラック/ホワイト) 入数:1
8,000円 W70×D85×H1200.3才 0.6kg 仕様/本体:スチ-ル 粉体塗装 (ブラック/ホワイト) 入数:1
AK:オーク
NA:ナチュラル
NDS-100(BK)
NDS-SF1(BK)
NDS-RR1(BK)
NDS-RR1(WH)
【使用例】
【使用例】
NDS-CS1(BK)
NDS-BP1(BK)
NDS-100(WH)
NDS-SF1(WH)
NDS-CS1(WH)
NDS-BP1(WH)
295 SOCIA
NPT




SPC 演台



演台 (プレゼンテーブル) 価格(税抜) サイズ(mm) 梱包才数梱包重量
NPT-BK 121,000円 W500×D460×H1000mm4.8才 15.4kg
NPT-WH 121,000円 W500×D460×H1000mm4.8才 15.4kg
仕様/天板:メラミン化粧板 脚:スチール(粉体塗装) 支柱:アルミ押出材・アルミ複合パネル 棚板:スチール(粉体塗装) キャスター:Φ50mmナイロン樹脂(ストッパー付2個、ストッパー無2個) 入数:1 ●配線ホール付2個 ●棚板サイズ:W350× D150mm

折畳み演台 価格(税抜)


サイズ(mm)梱包才数梱包重量
SPC-F12 300,000円 W1200×D500×H93012.7才 ▲ 33kg
SPC-F8 257,000円 W830×D500×H93010.6才26kg 仕様/天板:ダップ化粧板 ポストフォ-ム加工 本体:ダップ化粧板 ポストフォ-ム加工 入数:1 ●W1200サイズ折畳時:W1200×D200×H1000 ●W830サイズ折畳時:W830×D200×H1000


演台 価格(税抜)
サイズ(mm)梱包才数梱包重量
SPC-K12 170,000円 W1200×D445×H9507.7才 ▲ 30kg
SPC-K9 147,000円 W900×D445×H9505.3才21kg
仕様/天板:ダップ化粧板 ポストフォ-ム加工 本体:ダップ化粧板
折り畳み例 使用しないときは折畳んで コンパクトに収納すること ができます。





ポストフォ-ム加工 ステンレス目地入 入数:1
SPC-F12(RO)
SPC-F8(TE)
SPC-K12(RO)
SPC-K9(TE)
背面仕様
TE:チーク RO:ローズ ■カラーサンプル
ホスト側から見た斜視図 棚板付 TE:チーク RO:ローズ ■カラーサンプル
WH:ホワイト BK:ブラック
■天板カラーサンプル NA:ナチュラル
NPT-BK(BK)
NPT-WH(WH)
296
NPT-BK(NA)
司会者台
チェアデスク・収納パーティションテーブルレセプションロビーエクステリアアクセサリー木工


■カラーサンプル


司会者台 価格(税抜)サイズ(mm)梱包才数梱包重量
CMC-110 208,000円 W600×D450×H11006.6才25kg




無段階調整湾曲脚・アダプタ受け

配線ホール
講演台 (昇降タイプ) 価格(税抜) サイズ(mm)梱包才数梱包重量
NST-40 103,000円 W483×D440×H865~11673.9才14kg
仕様/天板:ダップ化粧板 ポストフォ-ム加工 本体:ダップ化粧板 ポストフォ-ム加工 キャスタ-4 ヶ所付 入数:1(2個口) ●棚板付
仕様/前板:スチ-ル 粉体塗装 (ホワイト) フレ-ム:スチ-ル 粉体塗装 (シルバ-) 天板:低圧メラミン化粧 板 (t18㎜) (ホワイト) ロ-カンエッジ仕上げ キャスタ-:ストッパ-付2個、ストッパ-無2個 入数:1 ●天板有 効寸法:W450×D380 ●上下スライドは無段階調節が可能 ●天板までの高さH648~950mm ●配線穴 付 ●配線受け付 ロックネジ付
電話台 サイドテーブル


電話台 価格(税抜)サイズ(mm)梱包才数梱包重量
KTL-451 51,000円 φ450×H8000.6才11.6kg
KTL-452 52,000円 φ450×H8000.6才11.6kg
仕様/天板:メラミン化粧板 (t20mm) ソフトエッジ仕上げ 支柱:スチ-ル (φ38.1mm) 粉体塗装 ベ-ス:スチ-ル板 粉体塗装 入数:1
プリンターラック



使用イメージ

H610~930まで、無段階 で高さ調節が可能です。
サイドテーブル 価格(税抜) サイズ(mm)梱包才数梱包重量
KU-45 45,000円 W450×D380×H610~9301.6才8.4kg
KU-60 48,000円 W600×D400×H610~9302.0才9.6kg
KU-75 51,000円 W750×D380×H610~9302.3才10.8kg
仕様/本体:スチ-ル 粉体塗装 (ホワイトグレ-) 天板:低圧メラミン化粧板 キャスタ-:φ50mm 入数:1 ●上下スライドは無段階調節が可能 ●支柱のロックネジによって、天板のぐらつきを抑えられます。

幼保レンタル・リース
プリンタラック 価格(税抜)サイズ(mm)梱包才数梱包重量 KNC-300L 55,000円 W600×D500×H3004.6才 13.5kg 仕様/フレ-ム:スチ-ル 角パイプ 粉体塗装 (ホワイトグレ-) 天板:スチ-ル板 粉体塗装 (ホワイトグレ-) 入数:1 ●デスク下に収納可能。 ●用紙収納スペ-ス有。
CMC-110(TE)
CMC-110(RO)
NST-40(WH) 外側
KNC-300L
KTL-451
KTL-452
KU-75
TE:チーク RO:ローズ
297 SOCIA

コートハンガー


コートハンガー 価格(税抜) サイズ(mm)梱包才数梱包重量
HK-1600
HK-1200
47,600円 W1600×D515×H16002.3才11kg
45,400円 W1200×D515×H16002.3才10kg
HK-900 44,300円 W900×D515×H16002.3才9kg
HK-600 42,200円 W600×D515×H16002.3才8kg
仕様/本体:スチ-ル 楕円パイプ (46×20mm) メラミン焼付塗装 (グレ-) ハンガ-パイプ:スチ-ル (φ25.4mm) クロ-ムメッキ φ40mm双輪キャスタ-付 入数:1 ●耐荷重80kg

コートハンガー 価格(税抜)サイズ(mm)梱包才数梱包重量
ACH-1700 38,000円 W300×D400×H17002.0才9kg
仕様/木部:MDF (突板貼り) 支柱:スチ-ル (40×20mm) メラミン焼付塗装 (シルバ-) ベ-ス:スチ-ル メラミン焼付塗装 (シルバ-) 入数:1 ●ハンガ-5本付




コートハンガー 価格(税抜) サイズ(mm)梱包才数梱包重量
HK-1600B 47,600円 W1600×D515×H16002.3才11kg
HK-1200B 45,400円 W1200×D515×H16002.3才10kg
HK-900B 44,300円 W900×D515×H16002.3才9kg
HK-600B 42,200円 W600×D515×H16002.3才8kg
仕様/本体:スチ-ル 楕円パイプ (40×20mm) 粉体塗装 (マットブラック) ハンガ-パイプ:スチ-ル (φ25.4mm) クロ-ムメッキ φ40mm双輪キャスタ-付 入数:1 ●耐荷重80kg

オプションハンガー (黒・5本セット) 価格(税抜)サイズ(mm)梱包才数梱包重量
ACHHANGA 4,000円 W420×D35×H2300.7才0.6kg
仕様/樹脂成型品 入数:1
HK-1200B
ACH-1700
ACHHANGA
HK-600B
HK-900B
HK-1600B
使用例
スタッキング例
HK-900
HK-1200
298
プランターハンガー
チェアデスク・収納パーティションテーブルレセプションロビーエクステリアアクセサリー木工

グリーン小鉢


G-IB
アイビー 10,500円(税抜) サイズ:W220×D220×H230mm 花器サイズ:上面/Φ100、底面/Φ60、高さ/80mm 葉 :ポリエステル+ポリエチレン 花 器:ポリプロピレン 入 数:1 梱包才数:0.2才 梱包重量:0.4kg ●光触媒


G-HIB
斑入りアイビー 10,500円(税抜) サイズ:W220×D220×H230mm 花器サイズ:上面/Φ100、底面/Φ60、高さ/80mm 葉 :ポリエステル+ポリエチレン 花 器:ポリプロピレン 入 数:1 梱包才数:0.2才 梱包重量:0.4kg ●光触媒
ラックは左右移動します。

■天板カラーサンプル

MAK:ミディアムオーク
プランターハンガー 価格(税抜) サイズ(mm)梱包才数梱包重量 PHN-1200(MAK) 98,000円 W1200×D515×H16003.8才20kg 仕様/コ-トハンガ-本体:スチ-ル 楕円パイプ (40×20mm) 粉体塗装 (マットブラック) ハンガ-パイプ:スチ -ル (φ25.4mm) クロ-ムメッキ キャスタ-:φ40mm双輪キャスタ- プランタ-本体:抗ウイルスメラミン化粧 板 抗ウイルスパッカ- 入数:1(2個口) ●器差込口:φ90 ●器差込口:6個付

G-SMG
ミックスグリーンS
13,200円(税抜) サイズ:W310×D250×H280mm 花器サイズ:上面/Φ100、底面/Φ60、高さ/80mm 葉 :ポリエステル+ポリエチレン 花 器:ポリプロピレン 入 数:1 梱包才数:0.6才 梱包重量:0.7kg ●光触媒

幼保レンタル・リース
G-MLL
ミニリーフL
16,500円(税抜) サイズ:W250×D250×H360mm 花器サイズ:上面/Φ100、底面/Φ60、高さ/80mm 葉 :ポリエステル+ポリエチレン 花 器:ポリプロピレン 入 数:1 梱包才数:0.6才 梱包重量:0.8kg ●光触媒

G-MLGW
ミニリーフG/W
10,500円(税抜) サイズ:W200×D200×H210mm 花器サイズ:上面/Φ100、底面/Φ60、高さ/80mm 葉 :ポリエステル+ポリエチレン 花 器:ポリプロピレン 入 数:1 梱包才数:0.2才 梱包重量:0.3kg ●光触媒
120 528 1454 Φ90 533 277 480 572 350 1200 1160 1356 116 1600 515
PHN-1200(MAK)
使用例
使用例
G-SMG
G-IB
G-HIB
G-MLL
G-MLGW
※特性上予告なく廃番になることがあります。 299 SOCIA
抗ウイルス 多目的スタンド

VT-30B/45B


エントランスや会議室での使用、 消毒台として様々な用途で使用が出来る多目的スタンド


抗ウイルス 多目的スタンド 価格(税抜)サイズ(mm)梱包才数梱包重量
VT-30B 35,000円 W300×D300×H7001.0才 5.7kg 仕様/天板:抗ウイルスメラミン化粧板 共張り 天板裏:抗ウイルスバッカ- フレ-ム:スチ-ル (〼19mm) メラミン焼付 塗装 (ブラック) 入数:1



抗ウイルス 多目的スタンド 価格(税抜)サイズ(mm)梱包才数梱包重量
VT-45B 39,000円 W450×D450×H7001.3才 9.4kg 仕様/天板:抗ウイルスメラミン化粧板 共張り 天板裏:抗ウイルスバッカ- フレ-ム:スチ-ル (〼19mm) メラミン焼付 塗装 (ブラック) 入数:1
■抗ウイルス 天板カラーサンプル


DBR:ダークブラウン



246 206 246 300 431 300 216 416 252 252 700 396 396 450 450 402 402 206 431 216 416 700
チェア MK-480(BK) P.109
VT-45B(DBR)
VT-30B(BR)
VT-45B(BR)
VT-45B(DBR)
VT-45B(NA)
VT-45B(WH)
VT-30B(DBR)
VT-30B(NA)
VT-30B(WH)
VT-30B
VT-45B
WH:ホワイト
NA:ナチュラル
BR:ブラウン
300
多目的スタンド
チェアデスク・収納パーティションテーブルレセプションロビーエクステリアアクセサリー木工



多目的スタンド 価格(税抜)サイズ(mm) 梱包才数梱包重量
T-30B塗装(ブラック) 33,000円 W300×D300×H7001.0才7kg
T-30N塗装(ナチュラル) 33,000円 W300×D300×H7001.0才7kg
T-30R塗装(ローズ) 33,000円 W300×D300×H7001.0才7kg
T-30T塗装(チーク) 33,000円 W300×D300×H7001.0才7kg
T-30W塗装(アイボリー) 33,000円 W300×D300×H7001.0才7kg
仕様/天板:メラミン化粧板(ローズ/チーク/アイボリー/ナチュラル/ブラック) フレ-ム:スチ-ル (〼19mm)
メラミン焼付塗装 (ブラック) 入数:1


多目的スタンド 価格(税抜)サイズ(mm) 梱包才数梱包重量
T-45B塗装(ブラック)
T-45N塗装(ナチュラル)
T-45R塗装(ローズ)
T-45T塗装(チーク)
T-45W塗装(アイボリー)
38,000円 W450×D450×H7001.5才11kg
38,000円 W450×D450×H7001.5才11kg
38,000円 W450×D450×H7001.5才11kg
38,000円 W450×D450×H7001.5才11kg
38,000円 W450×D450×H7001.5才11kg
仕様/天板:メラミン化粧板(ローズ/チーク/アイボリー/ナチュラル/ブラック) フレ-ム:スチ-ル (〼19mm) メラミン焼付塗装 (ブラック) 入数:1


多目的スタンド 価格(税抜)サイズ(mm) 梱包才数梱包重量
T-60B塗装(ブラック) 42,000円 W600×D450×H7001.5才13kg
T-60N塗装(ナチュラル) 42,000円 W600×D450×H7001.5才13kg
T-60R塗装(ローズ)
42,000円 W600×D450×H7001.5才13kg
T-60T塗装(チーク) 42,000円 W600×D450×H7001.5才13kg
T-60W塗装(アイボリー) 42,000円 W600×D450×H7001.5才13kg 仕様/天板:メラミン化粧板(ローズ/チーク/アイボリー/ナチュラル/ブラック) フレ-ム:スチ-ル (〼19mm) メラミン焼付塗装 (ブラック) 入数:1


多目的スタンド 価格(税抜)サイズ(mm) 梱包才数梱包重量
T-30Bメッキ(ブラック)
T-30Nメッキ(ナチュラル)
T-30Rメッキ(ローズ)
T-30Tメッキ(チーク)
T-30Wメッキ(アイボリー)
37,500円 W300×D300×H700 1.0才7kg
37,500円 W300×D300×H700 1.0才7kg
37,500円 W300×D300×H700 1.0才7kg
37,500円 W300×D300×H700 1.0才7kg
37,500円 W300×D300×H700 1.0才7kg
仕様/天板:メラミン化粧板 (ローズ/チーク/アイボリー/ナチュラル/ブラック) フレ-ム:スチ-ル (〼19mm)
クロ-ムメッキ 入数:1


多目的スタンド 価格(税抜)サイズ(mm) 梱包才数梱包重量
T-45Bメッキ(ブラック)
42,000円 W450×D450×H700 1.5才11kg
T-45Nメッキ(ナチュラル) 42,000円 W450×D450×H700 1.5才11kg
T-45Rメッキ(ローズ)
T-45Tメッキ(チーク)
T-45Wメッキ(アイボリー)
42,000円 W450×D450×H700 1.5才11kg
42,000円 W450×D450×H700 1.5才11kg
42,000円 W450×D450×H700 1.5才11kg
仕様/天板:メラミン化粧板(ローズ/チーク/アイボリー/ナチュラル/ブラック) フレ-ム:スチ-ル (〼19mm) クロ-ムメッキ 入数:1


幼保レンタル・リース
多目的スタンド 価格(税抜)サイズ(mm) 梱包才数梱包重量
T-60Bメッキ(ブラック) 48,000円 W600×D450×H700 1.5才13kg
T-60Nメッキ(ナチュラル) 48,000円 W600×D450×H700 1.5才13kg
T-60Rメッキ(ローズ) 48,000円 W600×D450×H700 1.5才13kg
T-60Tメッキ(チーク) 48,000円 W600×D450×H700 1.5才13kg
T-60Wメッキ(アイボリー) 48,000円 W600×D450×H700 1.5才13kg 仕様/天板:メラミン化粧板(ローズ/チーク/アイボリー/ナチュラル/ブラック) フレ-ム:スチ-ル (〼19mm) クロ-ムメッキ 入数:1
T-30R塗装(ローズ)
T-30T塗装(チーク)
T-30W塗装(アイボリー) T-30Nメッキ(ナチュラル)
T-30Bメッキ(ブラック)
T-45R塗装(ローズ)
T-45N塗装(ナチュラル)
T-60W塗装(アイボリー)
T-60B塗装(ブラック)
T-45Tメッキ(チーク)
T-45Wメッキ(アイボリー)
T-60Rメッキ(ローズ)
T-60Nメッキ(ナチュラル)
301 SOCIA
ダストボックス
S-DB

BTT


BTT説明(袋止めバインダー)
DB

BTT説明(袋止めバインダー取付例)

ゴミ箱としても、モノを入れる収納としても使える 抗菌素材の手編みカゴ。





ダストボックス 価格(税抜)サイズ(mm)梱包才数梱包重量
S-DB 9,000円 φ285×H3201.2才 1.2kg 仕様/本体:ポリプロピレン樹脂成型品+ポリエチレン樹脂成型品 入数:1 ●丸洗い可能



BTT-240(WH) 使用例
テーブルトラッシュ 袋止め付 価格(税抜)サイズ(mm)梱包才数梱包重量 BTT-240(BK/IV/WH) 29,000円 W240×D329×H6002.3才4.8kg 仕様/本体・トップパ-ツ:亜鉛メッキ鋼板 アクリル塗装 縁:ABS樹脂 底サッシュ:再生塩化ビニ-ル 入数:1 ●投函口:W197.6×H67.6 ●袋止めバインダ-4箇所付 位置は投入口下にあります。

ダストボックス 価格(税抜)サイズ(mm)梱包才数梱包重量
DB-1(BK/GR/SV) 33,500円 〼240×H6001.5才5.2kg 仕様/本体:スチ-ル アクリル塗装 フタ:スチ-ル アクリル塗装 中箱:スチ-ル 入数:1 ●中箱容量:20㍑



ダストボックス 価格(税抜)サイズ(mm)梱包才数梱包重量
DB-2(BK/GR/SV) 37,500円 W330×D240×H6002.0才6.1kg 仕様/本体:スチ-ル アクリル塗装 フタ:スチ-ル アクリル塗装 中箱:スチ-ル 入数:1 ●中箱容量:45㍑
BTT-240(BK)
BTT-240(IV)
DB-1(SV)
DB-2(BK)
DB-2(GR)
中箱(DB-1) 中箱(DB-2)
S-DB(WH)
S-DB(DGR) S-DB(LBJ)
S-DB(BR)
S-DB(LGR)
WJ-IN3(WH)
BTT-240(IV)
302
S-DB(WH)
機密書類回収ボックス
チェアデスク・収納パーティションテーブルレセプションロビーエクステリアアクセサリー木工



機密書類回収ボックス 価格(税抜)サイズ(mm)梱包才数梱包重量 BKM-220(SV/WH) 93,000円 W220×D300×H8002.9才12.3kg
仕様/本体:亜鉛メッキ鋼板 アクリル塗装 中容器:PP段ボ-ル 入数:1
●中箱サイズ:175×260×540 投函口:W20×H230 ●鍵2個付 ●分別ラベル付 170×55
スモーキングスタンド





機密書類回収ボックス 価格(税抜)サイズ(mm)梱包才数梱包重量 BKM-300(SV/WH) 112,000円 W300×D400×H8005.1才13kg 仕様/本体:亜鉛メッキ鋼板 アクリル塗装 中容器:PP段ボ-ル 入数:1
●中箱サイズ:245×360×570 投函口:W230×H30 ●鍵2個付 ●分別ラベル付 170×55

SK-1 33,000円 〼240×H6001.5才 4.2kg
仕様/本体:スチ-ル アクリル塗装 フタ:ステンレス ヘアライン仕上げ 入数:1
幼保レンタル・リース

スモーキングスタンド 価格(税抜)サイズ(mm)梱包才数梱包重量
BKM-220(SV)
BKM-300(WH)
SK-1(SV)
SK-1(BK)
SK-1(IV)
鍵付
分別ラベル付き
303 SOCIA
BKM-300(SV)
工具不要、かんたん組み立てが可能な二段ベッド。
EBD-B2


2段ベッド
2段ベッド 価格(税抜)サイズ(mm)梱包才数梱包重量
EBD-B2(SV) 141,800円 W965×L2085×H1710 ▲ 18.5才 ▲ 72kg 仕様/本体:スチ-ル (φ38.1mm) 粉体塗装 (シルバ-) 入数:1(3個口) (上段床面 H1300/下段床面 H360) マット部:W950×L2010 ●サイドレ-ル2個・ハシゴ1個付 ●マットレスは別売となります。
カーテンポイント
①防炎仕様 ②遮光性 ③ウォッシャブル
消防法施工規則に基づく防炎性能試験に合格した燃えにくい製品です。
遮光性を基準にした、光がもれにくいカーテンです。(遮光3級)
一般的な洗濯機で丸洗いができ、収縮がほとんどなく早く乾きます。

オプションサイドレー ル 価格(税抜)サイズ(mm)梱包才数梱包重量
EBD-B2-OS 4,300円 W820×D34×H3050.5才1.8kg
仕様/本体:スチ-ル 粉体塗装 (シルバ-) 入数:1

2段ベッド(カーテン3方向付)
2段ベッド (カーテン付) 価格(税抜)サイズ(mm) 梱包才数梱包重量
EBD-B2(SV)+ EBD-B2-OC(BJ/BL/GN)
238,000円 W965×L2085×H2250 ▲ 22.2才 ▲ 84kg 仕様/本体:スチ-ル (φ38.1mm) 粉体塗装 (シルバ-) 入数:1(6個口) (上段床面 H1300/下段床面 H360) マット部:W950×L2010 ●サイドレ-ル2個・ハシゴ1個・カ-テン付 ●マットレスは別売となります。 ●防炎・遮光3級カ-テン (大) 2枚、(小) 4枚 ●カ-テン付の組立てには工具が必要になります。
2段ベッド(カーテン4方向付)
2段ベッド (カーテン付) 価格(税抜)サイズ(mm) 梱包才数梱包重量 EBD-B2(SV)+
EBD-B2-OC(BJ/BL/BD)+ EBD-B2-OCOP(BJ/BL/GN)
295,000円 W965×L2085×H2250 ▲ 22.9才 ▲ 89kg 仕様/本体:スチ-ル (φ38.1mm) 粉体塗装 (シルバ-) 入数:1(8個口) (上段床面 H1300/下段床面 H360) マット部:W950×L2010 ●サイドレ-ル2個・ハシゴ1個・カ-テン付 ●マットレスは別売となります。 ●防炎・遮光3級カ-テン (大) 4枚、(小) 4枚 ●カ-テン付の組立てには工具が必要になります。
■カーテンカラーサンプル




ウレタンマットレス 価格(税抜)サイズ(mm)梱包才数梱包重量
MR-80 38,500円 W970×L2010×H80 ▲ 6.2才6.3kg
仕様/本体:布 (ポリエステル) クッション材:ウレタンフォ-ム 入数:1
EBD-B2(SV)+MR-80×2 マットレスは別売りとなります。
EBD-B2(SV)+EBD-B2-OC+MR-80×2 マットレスは別売りとなります。
分割使用
EBD-B2-OS(SV)
MR-80
GN:グリーン
BJ:ベージュ BL:ブルー
ベッド 304
2段ベッド
KBS-203
チェアデスク・収納パーティションテーブルレセプションロビーエクステリアアクセサリー木工




上下キャップは別売りとなります。
マットレス




スチール2段ベッド 価格(税抜)サイズ(mm)梱包才数梱包重量
KBS-203 199,000円 W910×L1980×H1830 ▲ 11.2才54kg
仕様/フレ-ム:スチ-ル (φ32mm) 粉体塗装 床枠:3×40mm アングル鋼 ボトム:フ-プ張り 入数:1(2個口) ●床面 H360/床下 H310 ●マット部:W830×L1890 ●サイドレ-ル・ハシゴ付 ●マットレスは別売となります。 ●各段静荷重120kg
スチール2段ベッド (カーテン付) 価格(税抜)サイズ(mm)梱包才数梱包重量
KBS-203C 336,000円 W910×L1980×H2235 ▲ 12.8才63kg
仕様/フレ-ム:スチ-ル (φ32mm) 粉体塗装 床枠:3×40mm アングル鋼 ボトム:フ-プ張り
入数:1(4個口) ●床面 H360/床下 H310 ●マット部:W830×L1890
●サイドレ-ル・ハシゴ・三方防炎カ-テン付 (ブル-) ●マットレスは別売となります。 ●各段静荷重120kg
サイドレール 価格(税抜)サイズ(mm)梱包才数梱包重量
KBS-203R 17,000円 W300×D785×H400.5才2kg
仕様/本体:スチ-ル 粉体塗装 入数:1
ウレタンマットレス 価格(税抜)サイズ(mm)梱包才数梱包重量
KBM-301 58,000円 W900×L1900×H80 ▲ 5.4才9.3kg
仕様/中材:ウレタン カバ-:ポリエステル100% 入数:1
チップウレタン マットレス 価格(税抜)サイズ(mm)梱包才数梱包重量
KBM-302L 75,000円 W905×L1950×H80 ▲ 5.7才10.2kg
仕様/中材:ウレタン カバ-:ポリエステル100% 入数:1
スタイロボードタタミ 価格(税抜)サイズ(mm)梱包才数梱包重量 KBM-401L 55,000円 W905×L1950×H35 ▲ 3.3才10.5kg
仕様/中材:ポリエステルスチレンボ-ド 表地:天然い草 入数:1
 KBM-301
KBM-401L
KBS-203 + KBM-301(×2)
KBS-203C + KBM-301(×2)
KBS-203R 1段ベッドとしても使用できます。
KBM-302L
マットレスは別売りとなります。
KBM-301
KBM-401L
KBS-203 + KBM-301(×2)
KBS-203C + KBM-301(×2)
KBS-203R 1段ベッドとしても使用できます。
KBM-302L
マットレスは別売りとなります。
305 SOCIA
マットレスは別売りとなります。
幼保レンタル・リース

KBS-212 + KBM-302L(×2)

KBS-212CG + KBM-401L(×2)
■カラーサンプル



1段ベッドとしても使用できます。 1段ベッドとして使用する場合 は別途、上下キャップが必要 となります。ご利用の方はお問 い合わせください。
スチール2段ベッド 価格(税抜)サイズ(mm)梱包才数梱包重量 KBS-212 282,000円 W990×L2050×H186028.0才79kg 仕様/フレ-ム:スチ-ル (φ42mm) 粉体塗装 床枠:角パイプ (60×30mm) 粉体塗装 ボトム:メッシュ張り 入数:1(2個口) ●床面 H350/床下 H290 ●マット部:W930×L1880 ●サイドレ-ル・ハシゴ付 ●マットレス・タタミ別売 ●各段静荷重160kg
KBS-212CB + KBM-401L マットレスは別売りとなります。 マットレスは別売りとなります。
スチール2段ベッド 価格(税抜)サイズ(mm)梱包才数梱包重量
KBS-212CG 385,000円 W990×L2050×H226028.0才89kg 仕様/フレ-ム:スチ-ル (φ42mm) 粉体塗装 床枠:角パイプ (60×30mm) 粉体塗装 ボトム:メッシュ張り 入数:1(2個口) ●床面 H350/床下 H290 ●マット部:W930×L1880 ●サイドレ-ル・ハシゴ付 ●マットレス・タタミ別売 ●カ-テンカラ-:グリ-ン ●各段静荷重160kg
ベッド KBS-212 KBS-103



マットレスは別売りとなります。

マットレスは別売りとなります。
■カラーサンプル

スチール2段ベッド 価格(税抜)サイズ(mm)梱包才数梱包重量 KBS-212CB 385,000円 W990×L2050×H186028.0才89kg 仕様/フレ-ム:スチ-ル (φ42mm) 粉体塗装 床枠:角パイプ (60×30mm) 粉体塗装 ボトム:メッシュ張り 入数:1(2個口) ●床面 H350/床下 H290 ●マット部:W930×L1880 ●サイドレ-ル・ハシゴ付 ●マットレス・タタミ別売 ●カ-テンカラ-:ベ-ジュ ●各段静荷重160kg
KBS-212用 サイドレール 価格(税抜)サイズ(mm)梱包才数梱包重量 KBS-202R 31,000円 W872×D22×H3000.6才3kg 仕様/本体:スチ-ル 粉体塗装 入数:1
KBS-212用 床固定金具 価格(税抜)サイズ(mm)梱包才数梱包重量 KBS-201LK 24,000円 W25×D50×H780.2才 1.4kg 仕様/本体:スチ-ル 床枠:角パイプ (60×30mm) 粉体塗装 入数:1 ●4個1組

スチール1段ベッド 価格(税抜) サイズ(mm)梱包才数梱包重量 KBS-103 172,000円 W980×L2070×H900 (BH450) 13.4才27kg 仕様/フレ-ム:スチ-ル (φ38.1mm) 粉体塗装 床枠:角パイプ (60×30mm) 粉体塗装 ボトム:メッシュ張り 入数:1 ●マットレス・タタミは別売となります。 ●静荷重150kg
KBS-202R
KBS-201LK
グリーン
KBS-103 + KBM-301
ベージュ
306
チェアデスク・収納パーティションテーブルレセプションロビーエクステリアアクセサリー木工

ベッド WBD-V02(NA)

木製ベッド 価格(税抜)サイズ(mm)梱包才数梱包重量
WBD-V02
79,000円 W985×L2025×H7107.9才32kg
仕様/フレ-ム:合板 (ポプラ突板) /天然木 (ラバ-ウッド) 塗装 マット:天然木 布張り (ナイロン100%) 入数:1(2個口) ●床面 H325/床下 H215 ●床下有効寸法:W1945×D980×H165mm ●静荷重100kg

オプション引き出し 価格(税抜)サイズ(mm)梱包才数梱包重量 WBD-VHD 46,000円 W965×D475×H2058.5才14kg 仕様/本体:合板 (ポプラ突板) 塗装 入数:1(2個口) ●引出内寸:W905×L430×H150
●収納部有効寸法:W905×D430×H150mm




幼保レンタル・リース
通気性が良く、耐久性に 優れたボンネルコイルスプ リングを使用しています。

張地は、繊維が丈夫で ホコリも立ちにくいポリエ ステル100%を使用して います。
スプリングマット (シングル) 価格(税抜) サイズ(mm) 梱包才数梱包重量
MRS-13 41,000円 W970×L1950×H130 ▲ 10.0才 17kg
仕様/張地:布 (ポリエステル100%) クッション材:コイルスプリング (線径2.25mm、248個) 入数:1
チェア K-926(GR) P.093
WBD-V02(NA)+WBD-VHD(NA)
ACH-1700
WBD-V02(NA)
WBD-VHD(NA)
MRS-13
WBD-V02設置例 キャスター付
307 SOCIA
工具不要! かんたん組み立てが可能なシングルベッド。

イージーベッド 価格(税抜)サイズ(mm)梱包才数梱包重量
EBD-02(BR) 49,600円 W965×L2085×H6705.1才28kg
仕様/フレ-ム:スチ-ル (φ38.1mm) 粉体塗装 (ブラウン) マット:合板 布張り (ナイロン100% ブラウン) 入数:1(2個口) ●有効寸法:床面H400/床下H310 ●マット部:W950×L2000 ●床下有効寸法: W1920×D965×H310mm

スプリングマット (シングル) 価格(税抜) サイズ(mm)梱包才数梱包重量
MRS-13 41,000円 W970×L1950×H130 ▲ 10.0才17kg
仕様/張地:布 (ポリエステル100%) クッション材:コイルスプリング (線径2.25mm、248個) 入数:1
バゲージラック

バゲージラック 価格(税抜)サイズ(mm)梱包才数梱包重量 RKA-410 20,000円 W470×D410×H4105.6才7.5kg 仕様/フレ-ム:アルミ (φ19mm) アルマイト仕上げ ベルト:ナイロン (ブラック) 入数:5

工具要らずの簡易組立て仕様です。

通気性が良く、耐久性に優れた ボンネルコイルスプリングを使用 しています。

張地は、繊維が丈夫でホコリも 立ちにくいポリエステル100% を使用しています。

バゲージラック 価格(税抜)サイズ(mm)梱包才数梱包重量 RKW-455 36,000円 W470×D410×H4555.3才12.9kg 仕様/フレ-ム:ラバ-ウッド ベルト:ナイロン (ブラック) 入数:5
EBD-02
EBD-02(BR)
MRS-13
RKA-410
RKW-455
308
金庫
耐火
ダイヤル式
チェアデスク・収納パーティションテーブルレセプションロビーエクステリアアクセサリー木工

テンキー式
先進機能のロックシステムで、暮らしの安心を守ります。

指紋照合式

ICカードロック式

機能で選べる多彩なロックシステムは全部で4種類。


ダイヤル式
金庫といえばこのロック。手間のかかる解錠で、防犯性 に優れています。ダイヤルを左右に回し、設定された数 字で止めることを繰り返し解錠します。
テンキー式
・ 1~10桁までの1種類の暗証番号を自由に設定・変 更が行えます。 ※個人の暗証番号を1種類設定できます。
・「暗証番号探り」による不正解錠を防止するため、 誤った暗証番号を5回入力すると約15分間はテン キー操作を受け付けません。

KOSS-C 220,000円 W484×D489×H372 3.8才 ▲ 56.5kg
KOSS-D 112,000円 W484×D489×H372 3.8才 ▲ 56.5kg
KOSS-E 146,000円 W484×D489×H372 3.8才 ▲ 56.5kg
KOSS-F 188,000円 W484×D489×H372 3.8才 ▲ 56.5kg
仕様/本体:スチ-ル 粉体塗装 トレ-:樹脂成型品 付属品:トレ-1枚 トレ-内寸:W344×D214×H42mm 入数:1 ●容量:19.5㍑
金庫 価格(税抜) サイズ(mm) 梱包才数梱包重量
KONS-C 283,000円 W330×D513×H603 4.5才 ▲ 63kg
KONS-D 220,000円 W330×D513×H603 4.5才 ▲ 63kg
KONS-E 240,000円 W330×D513×H603 4.5才 ▲ 63kg
KONS-F 280,000円 W330×D513×H603 4.5才 ▲ 63kg
仕様/本体:スチ-ル 粉体塗装 トレ-:スチ-ル 付属品:トレ- (L) 1枚、トレ- (S) 1枚
トレ-内寸:(L) W220×D300×H80mm (S) W220×D300×H45mm 入数:1 ●容量:37㍑
金庫 価格(税抜) サイズ(mm) 梱包才数梱包重量
KOSD-C 350,000円 W457×D567×H663 7.2才 ▲ 100kg
KOSD-D 240,000円 W457×D567×H663 7.2才 ▲ 100kg
KOSD-E 280,000円 W457×D567×H663 7.2才 ▲ 100kg
KOSD-F 315,000円 W457×D567×H663 7.2才 ▲ 100kg 仕様/本体:スチ-ル 粉体塗装 棚板:スチ-ル 粉体塗装 付属品:棚板1枚、鍵付引出1個 引出内寸:W297×D260×H77mm 入数:1 ●容量:51.5㍑ 金庫 価格(税抜) サイズ(mm) 梱包才数梱包重量
搬入設置・階段上げの場合は、別途お見積り致します。


指紋照合式 指紋認証には、コンパクトな指紋リーダーで多くの指紋 情報を読み込める「スライド式」を採用しています。人数 や指の種類を問わず10指までの登録が可能です。 ※万一を想定して、1人2指の登録を勧めています。
ICカードロック式 (FeliCa 対応)
・FeliCaに対応しているICカード・携帯電話を「ユーザー カード」としてロックシステムに10枚まで登録可能で す。操作性と信頼性の高いセキュリティです。
・履歴情報を約500件分記憶し、使用者の特定と使用 時刻管理が可能です。また、データをパソコンに移すこ とにより、閲覧・保存・印刷が可能です。

金庫 価格(税抜)サイズ(mm)梱包才数梱包重量
KLK-304 64,000円 W416×D320×H2551.7才6kg 仕様/本体:スチ-ル 粉体塗装 (アイボリ-) 内寸 (1扉):W160×D300×H87mm 入数:1


金庫 価格(税抜)サイズ(mm)梱包才数梱包重量
KBES-2EH 98,000円 W410×D369×H2131.4才21kg 仕様/本体:スチ-ル 粉体塗装 (ダ-クグレ-) 付属品:単3形乾電池4本 内寸:W330×D230×H105mm 入数:1 ●容量:8.3㍑ ●テンキ-式
金庫 価格(税抜)サイズ(mm)梱包才数梱包重量
KBES-2 52,000円 W410×D347×H2131.4才21kg 仕様/本体:スチ-ル 粉体塗装 (ダ-クグレ-) 付属品:トレ-1枚 内寸:W330×D240×H105mm 入数:1 ●容量:8.3㍑ ●シリンダ-式
金庫 価格(税抜)サイズ(mm)梱包才数梱包重量 KLK-308 100,000円 W416×D320×H4853.0才11.9kg
仕様/本体:スチ-ル 粉体塗装 (アイボリ-) 内寸 (1扉):W160×D300×H87mm 入数:1 ●付属:番号検索キ-1本 ●耐火性能はございません。

幼保レンタル・リース

金庫 価格(税抜)サイズ(mm)梱包才数梱包重量 KLK-408-1 62,000円 W375×D421×H2181.7才8.5kg
仕様/本体:スチ-ル 粉体塗装 (ブラック) 扉:グレ- 内寸:W300×D357×H158mm 入数:1 ●4ヶ国 語の操作説明書付 (日本語・英語・韓国語・中国語) ●タブレットやノ-トパソコン収納可能な目安サイズは14 インチ程度 ●錠前:4桁のお好きな番号をダイヤル設定して施解錠。ツマミを回すとダイヤルが“0”に戻り、設定 番号の盗難防止。
KOSS-D
KOSS-F
KOSS-E
KOSS-C
KBES-2EH
KBES-2
KLK-408-1
KLK-304
KLK-308
309 SOCIA










400 380 Φ350 Φ220 抗菌サークルボックス 価格(税抜) サイズ(mm) 梱包才数梱包重量 CoMbI。 15,000円 φ350×H400mm 8.3才 8.5kg 仕様/本体:ポリプロピレン樹脂成型品+ポリエチレン樹脂成型品 入数:6
CoMbⅠ。(LGR)+G-TN18
CoMbⅠ。(DGR)+G-OVT126
DGR:ダークグレー LGR:ライトグレー
CoMbⅠ。 CoMbI。(DBR) CoMbI。(LBJ) CoMbI。(LGR) CoMbI。 310
LBJ:ライトベージュ
■カラーサンプル


抗菌手編みバスケット Sシリーズ
安心を編む。100%抗菌PP+PE素材





Point ①丸洗いOK
②SIAA規格をクリアした抗菌 素材を使用 ③しっかりした作りで丈夫 ④ささくれないから収納に最適 ⑤ムダのないシンプルなデザイン





ダストボックス 価格(税抜)サイズ(mm)梱包才数梱包重量
S-DB 9,000円 φ285×H3201.2才 1.2kg
仕様/本体:ポリプロピレン樹脂成型品+ポリエチレン樹脂成型品 入数:1 ●丸洗い可能






スクェアバスケット 価格(税抜)サイズ(mm)梱包才数梱包重量
S-SB 13,800円 W370×D280×H3601.7才1.5kg
仕様/本体:ポリプロピレン樹脂成型品+ポリエチレン樹脂成型品 入数:1 ●丸洗い可能





オーバルバスケット 価格(税抜)サイズ(mm)梱包才数梱包重量
S-OB 17,500円 W470×D340×H3502.3才1.6kg
仕様/本体:ポリプロピレン樹脂成型品+ポリエチレン樹脂成型品 入数:1 ●丸洗い可能





ストレージかご 価格(税抜)サイズ(mm)梱包才数梱包重量
ランドリーボックス 価格(税抜)サイズ(mm)梱包才数梱包重量 S-LB 17,500円 W410×D310×H5302.8才2.2kg 仕様/本体:ポリプロピレン樹脂成型品+ポリエチレン樹脂成型品 入数:1 ●丸洗い可能
S-SK 13,000円 W410×D310×H2301.2才1.4kg 仕様/本体:ポリプロピレン樹脂成型品+ポリエチレン樹脂成型品 入数:1 ●丸洗い可能
S-LB(DGR)
S-SK(LGR)
S-LB(WH) S-LB(LGR) S-LB(LBJ) S-LB(BR)
S-SK(DGR) S-SK(WH)
S-SK(LBJ) S-SK(BR)
S-SB(LBJ)
S-SB(WH) S-SB(LGR) S-SB(DGR) S-SB(BR) S-OB(WH) S-OB(LGR)
S-OB(DGR) S-OB(LBJ)
S-OB(BR)
S-DB(WH) S-DB(DGR) S-DB(LBJ) S-DB(BR)
S-DB(LGR)
ASO-WCF-NA(GJ)
ASO-CF750W(NA) S-SK(LBJ)
311 SOCIA
チェアデスク・収納パーティションテーブルレセプションロビーエクステリアアクセサリー木工 幼保レンタル・リース
ソファベッド


ZSB-1650(PK)
背もたれを倒せば、簡易ベッドにもできる。 1台で腰掛とベッドになる2wayソファ。
ベッド仕様


ZSB-1800(PK)
ソファベッド 価格(税抜) サイズ(mm) 梱包才数梱包重量
ZSB-1650 148,000円 ソファ時:W1650×D815×H735 (SH380) ▲ 10.4才 ▲ 34kg
ZSB-1800 188,000円 ソファ時:W1820×D815×H735 (SH380) ▲ 11.2才 ▲ 37kg 仕様/本体:木枠 合成皮革張り (PVC) 脚:スチ-ル 粉体塗装 (ホワイト) 入数:1 ●ベッド時:D870 ●リクライニング機能:4段階
診察台


ワンタッチで折り畳み可能な簡易的折り畳みベッド キャスター付きで移動も可能。


折畳みベッド 価格(税抜)サイズ(mm)梱包才数梱包重量
Y-OB 193,000円 W1810×D760×H61018.5才 ▲ 30kg
仕様/座:合板 ウレタンフォ-ム+チップウレタン 合成皮革張り (PVC) フレ-ム:スチ-ル 粉体塗装 (アイボリ-) キャスタ-:ゴムキャスタ- (ストッパ-付4個) 入数:1




折畳用ツマミ 折畳施錠時 折畳解除時
折畳用ツマミ(引き)





380 1160 1650 233 549 870 1282 671 815 440 735 380 1160 1650 233 549 1282 671 440 735 870 380 629629 1820 233 549 870 1441 671 815 440 735 380 629629 1820 233 549 1441 671 440 735 870 760 556556 1810 365 620 1490 360 610 1160
←
リクライニング
ソファ時 ベッド時
Y-OB(BL)
ZSB-1650
ZSB-1800
Y-OB(GN)
Y-OB(BL)
BK:ブラック
IV:アイボリー GN:グリーン BL:ブルー
■カラーサンプル
312
PK:ピンク ■カラーサンプル 安全ロック 折畳仕様
チェアデスク・収納パーティションテーブルレセプションロビーエクステリアアクセサリー木工


取っ手とストッパーつきキャスターがどちら側に もありますので、狭い通路でも方向転換の 必要がありません。


4輪ともストッパー付きキャスターを採用。 棚板は取り外す事が可能です。

脱衣カゴ

脱衣カゴ 価格(税抜)サイズ(mm)梱包才数梱包重量
TDK-03 32,000円 W525×D370×H7554.4才5kg
仕様/フレ-ム:スチ-ル (φ19.1mm) 粉体塗装 カゴ:ポリプロピレン樹脂 入数:1
●カゴ寸法:W510×D370×H185mm
ワゴン 価格(税抜)サイズ(mm)梱包才数梱包重量 WGN-3 78,000円 W460×D750×H9805.7才19kg 仕様/フレ-ム:スチ-ル (φ25.4mm) クロ-ムメッキ 棚板:スチ-ル メラミン焼付塗装 入数:1 ●棚板脱 着可能 ●棚寸法:W410×D690×H20mm ●有効内寸:(中段・下段) W410×D690×H295mm
ランドリーボックス





ランドリーボックス 価格(税抜)サイズ(mm)梱包才数梱包重量
S-LB 17,500円 W410×D310×H5302.8才2.2kg
仕様/本体:ポリプロピレン樹脂成型品+ポリエチレン樹脂成型品 入数:1 ●丸洗い可能

幼保レンタル・リース
脱衣カゴ 価格(税抜)サイズ(mm)梱包才数梱包重量
TDK-04 32,000円 W525×D370×H7554.4才5kg
仕様/フレ-ム:スチ-ル (φ19.1mm) 粉体塗装 カゴ:ポリプロピレン樹脂 入数:1
●カゴ寸法:W510×D370×H185mm
WGN-3
TDK-03(BL)
TDK-04(WH)
S-LB(DGR)
S-LB(WH)
S-LB(LGR)
S-LB(LBJ)
S-LB(BR)
ワゴン
313 SOCIA
S-LB(LGR)
Kindergarten

木 工 家 具
一貫した生産管理のもとで安定した品質を 維持しオリジナリティのある製品づくりを 目指します。

314
Woodworking Welfare
レンタル・リース
Rental / Lease
主要設備紹介
チェアデスク・収納パーティションテーブルレセプションロビーエクステリアアクセサリー木工



PNC複合ボーリングマシン ボーリング機能から面取り・サイドカッターなど様々な加工ができるマルチ複合マシン


パーフェクトエッジバンディング ストリーマー 1057
ホルツヘル社の技術と経験・実績が作った高性能なエッジバインダー縁張機

大型パネルソー
10尺サイズの大きな板面を切断できるパネルソー。
大型の天板やパーティションの生産が可能。



パネルソー
標準的な8尺サイズの 板面を切断するパネルソー

糊付機
木工に必要な糊付けを行う糊付機。
 プレス機 最大8tの圧で部材加工が可能なプレスマシン。
プレス機 最大8tの圧で部材加工が可能なプレスマシン。
315 SOCIA
幼保レンタル・リース


縫製部門

アコーディオンスクリーン等の

パネル製作

作業風景
別注、別色、別張り、別寸など、多品種・小ロットで �お客様の様々なニーズにあった家具の製造を承ります。

学習デスク


個別学習デスク
抗ウイルス ソフトエッジ

大講義室用教壇

木
裁断機
施設用脱衣所棚
1700㎜サイズの生地をカットできる裁断機。 アコーディオンスクリーン等の生産が可能。
316
縫製を自社で行っております。






木 工 家 具
 鹿児島実業高等学校
某公共施設
長崎市役所 新庁舎
長崎市役所 新庁舎
美容室・サロンの受付カウンター
鹿児島実業高等学校
某公共施設
長崎市役所 新庁舎
長崎市役所 新庁舎
美容室・サロンの受付カウンター
317 SOCIA
某私立大学
納入事例
チェアデスク・収納パーティションテーブルレセプションロビーエクステリアアクセサリー木工
幼保レンタル・リース
抗ウイルス 学習デスク

GD-P
チェア
SFIDA(GN) P.108


WH:ホワイト GN:グリーン NA:ナチュラル MAK:ミディアムオーク BR:ブラウン ■カラーサンプル












抗ウィルス学習個別 デスク 価格(税抜)サイズ(mm)梱包才数梱包重量
GD-P8060 219,000円 W800×D600×H12003.4才 57.8kg
仕様/本体:抗ウイルスメラミン化粧板 (t22mm) 抗ウイルスABSエッジ 入数:1(3個口)
800 756 336 600 320 100 1200 378 700 11 0 550 200 250
GD-P8060(BR)
GD-P8060(GN)
GD-P8060(WH)
GD-P8060(MAK)
GD-P8060
GD-P8060(NA)
318
チェアデスク・収納パーティションテーブルレセプションロビーエクステリアアクセサリー木工

チェア
SFIDA(GN) P.108





GD-O/GD-S



WH:ホワイト GN:グリーン NA:ナチュラル MAK:ミディアムオーク BR:ブラウン ■カラーサンプル







幼保レンタル・リース
抗ウイルス学習デスク 価格(税抜)サイズ(mm)梱包才数梱包重量
GD-O7045 170,000円 W700×D450×H7001.9才28.8kg
仕様/本体:抗ウイルスメラミン化粧板 (t22mm) 抗ウイルスABSエッジ 入数:1(2個口)
抗ウイルス学習デスク 専用仕切りパネル 価格(税抜)サイズ(mm)梱包才数梱包重量
GD-S1200 51,000円 W22×D500×H12001.0才12.9kg
仕様/本体:抗ウイルスメラミン化粧板 (t22mm) 抗ウイルスABSエッジ 入数:1
656 700 100 700 556 178 250 450 22 1200 500
SOCIA G-TN18 P.070
GD-O7045(別注BL)
GD-S1200(別注BL)
GP-O7045
GD-S1200
GP-O7045(WH)
GP-O7045(BR)
GP-O7045(NA)
GD-S1200(MAK)GD-S1200(GN)
319 SOCIA






SHE-04/W900mm





シェルフ 価格(税抜)サイズ(mm)梱包才数梱包重量
SHE-04 166,000円 W900×D400×H95012.6才 33kg 仕様/天板:抗ウイルスメラミン化粧板 エッジ:共張り (抗ウイルス) 本体:抗ウイルスメラミン化粧板 キャスタ-:φ 75mm双輪ナイロンキャスタ- 入数:1 ●キャスタ-:ストッパ-付4個
SHE-06/W1200mm


シェルフ 価格(税抜)サイズ(mm)梱包才数梱包重量
SHE-06 217,000円 W1200×D400×H95016.7才

419 419 900 396 400 950 398 401 401 88 372 372372 1200 396 400 950 398 401 401 88
仕様/天板:抗ウイルスメラミン化粧板 エッジ:共張り
75mm双輪ナイロンキャスタ- 入数:1 ●キャスタ-:ストッパ-付4個、ストッパ-無1個 シェルフ
43kg
(抗ウイルス) 本体:抗ウイルスメラミン化粧板 キャスタ-:φ
SHE-04(NA)
SHE-06(MAK)
SHE-04(NA)
SHE-06(NA)
SHE-06(DBR)
SHE-06(MAK)
SHE-04(DBR)
SHE-06
SHE-04
WH:ホワイト NA:ナチュラル MAK:ミディアムオーク DBR:ダークブラウン BR:ブラウン ■カラーサンプル 320
SHE-04(MAK)
ストッパー付キャスター
組立式ユニットカウンター
チェアデスク・収納パーティションテーブルレセプションロビーエクステリアアクセサリー木工

組立手順 ①幕板取付


③天板取付 ②棚板取付 ④完成

組立式ユニットカウンター
仕様/天板:メラミン化粧板 側板・幕板・棚板:ポリ化粧板 エッジ:メラミン化粧板 入数:1(3個口)
組立式ユニットカウンター 価格(税抜) サイズ(mm)梱包才数梱包重量
UNC-H1570T(BK)
UNC-H1570T(WH)
円
仕様/天板:メラミン化粧板 側板・幕板・棚板:ポリ化粧板 エッジ:メラミン化粧板 入数:1(3個口)
組立式ユニットカウンター 価格(税抜) サイズ(mm)梱包才数梱包重量
UNC-H1260T(BK) 170,000円
UNC-H1260T(WH) 158,000円
W1200×D600×H9004.3才28kg
W1200×D600×H9004.3才28kg
仕様/天板:メラミン化粧板 側板・幕板・棚板:ポリ化粧板 エッジ:メラミン化粧板 入数:1(3個口)





幼保レンタル・リース
900 6132 11 1200 600 1098 550 350137 900 6132 11 1500 700 1398 650 400137 900 6132 11 1800 700 1698 650 400137
212,000
W1500×D700×H9005.6才33kg
193,000円 W1500×D700×H9005.6才33kg
価格(税抜) サイズ(mm)梱包才数梱包重量 UNC-H1870T(BK) 230,000円 W1800×D700×H900 ▲ 7.2才 ▲ 37kg UNC-H1870T(WH) 210,000円 W1800×D700×H900 ▲ 7.2才 ▲ 37kg
UNC-H1870T(WH)
UNC-H1570T(WH)
UNC-H1260T(BK)
UNC-H1870T
UNC-H1260T
BK:ブラック ■カラーサンプル 321 SOCIA
UNC-H1570T
WH:ホワイト
プランターハンガー

グリーン

G-SMG
ミックスグリーンS
13,200円(税抜)
サイズ:W310×D250×H280mm 花器サイズ:上面/Φ100、底面/Φ60、 高さ/80mm
葉 :ポリエステル+ポリエチレン 花 器:ポリプロピレン 入 数:1 梱包才数:0.6才 梱包重量:0.7kg
●光触媒
ラックは左右移動します。

PHN-1200(MAK)

プランターハンガー 価格(税抜) サイズ(mm) 梱包才数梱包重量 PHN-1200(MAK) 98,000円 W1200×D515×H16003.8才 20kg
仕様/コ-トハンガ-本体:スチ-ル 楕円パイプ (40×20mm) 粉体塗装 (マットブラック) ハンガ-パイプ:スチ-ル (φ25.4mm)
クロ-ムメッキ キャスタ-:φ40mm双輪キャスタ- プランタ-本体:抗ウイルスメラミン化粧板 抗ウイルスパッカ- 入数:1(2個口) ●器差込口:φ90 ●器差込口:6個付

G-IB
アイビー
10,500円(税抜)
サイズ:W220×D220×H230mm 花器サイズ:上面/Φ100、底面/Φ60、 高さ/80mm
葉 :ポリエステル+ポリエチレン
花 器:ポリプロピレン
入 数:1 梱包才数:0.2才 梱包重量:0.4kg
●光触媒

G-HIB
斑入りアイビー
10,500円(税抜)
サイズ:W220×D220×H230mm 花器サイズ:上面/Φ100、底面/Φ60、 高さ/80mm
葉 :ポリエステル+ポリエチレン
花 器:ポリプロピレン
入 数:1 梱包才数:0.2才 梱包重量:0.4kg
●光触媒


G-MLL
ミニリーフL
16,500円(税抜)
サイズ:W250×D250×H360mm 花器サイズ:上面/Φ100、底面/Φ60、 高さ/80mm
葉 :ポリエステル+ポリエチレン 花 器:ポリプロピレン
入 数:1 梱包才数:0.6才 梱包重量:0.8kg ●光触媒

G-MLGW
ミニリーフG/W
10,500円(税抜)
サイズ:W200×D200×H210mm 花器サイズ:上面/Φ100、底面/Φ60、 高さ/80mm
葉 :ポリエステル+ポリエチレン
花 器:ポリプロピレン
入 数:1 梱包才数:0.2才 梱包重量:0.3kg
●光触媒


120 528 1454 Φ90 533 277 480 572 350 1200 1160 1356 116 1600 515 プランターアクリル
価格(税抜)サイズ(mm)梱包才数梱包重量 PPN-920 189,000円 W900×D200×H5003.2才7kg 仕様/葉:ポリエステル+ポリエチレン 花器:抗ウイルスメラミン化粧板 パネル:アクリル (t2.0mm) 入数:1(2個口)
パネル
G-SMG
G-IB
G-HIB
G-MLL
G-MLGW
プランターアクリルパネル 配線収納用スペース
ASO-HC320C(GR)
ASO-HC320C(NA)
ASO-WH1811B(MAK)
322
PPN-920(MAK)
プランターボックス
チェアデスク・収納パーティションテーブルレセプションロビーエクステリアアクセサリー木工
ASO-PB






CKH22+CKH22-AR+CKH22-HR
■カラーサンプル

BR:ブラウン

プランターボックス (ハイタイプ) 価格(税抜) サイズ(mm)梱包才数梱包重量
ASO-PB1530H 218,000円 W1500×D300×H11004.5才
▲ 70kg 仕様/本体:パーティクルボード 抗ウイルスメラミン化粧板(t22mm)ABSエッジ 抗ウイルスABSエッジ(SGRは 通常ABS) 入数:1

NA:ナチュラル MAK:ミディアムオーク



WH:ホワイト SGR:ストーングレー

プランターボックス (ロータイプ) 価格(税抜) サイズ(mm)梱包才数梱包重量
ASO-PB1530L 175,000円 W1500×D300×H8003.3才
幼保レンタル・リース
▲ 54kg
仕様/本体:パーティクルボード 抗ウイルスメラミン化粧板(t22mm)ABSエッジ 抗ウイルスABSエッジ(SGRは 通常ABS) 入数:1
800 1500 300 プランター内寸:W1460×D256×H5/150/180 1100 1500 300 プランター内寸:W1460×D256×H5/150/180
ASO-PB1530L ASO-PB1530H
ASO-PB1530H(NA)
ASO-BLS(IV)
ASO-T1575(NA)
ASO-PB1530L(NA)
ASO-PB1530H(BR)
323 SOCIA
ASO-PB1530L(NA)
ベンチシステム

自由な発想でロビー・エントランスを彩るベンチシステム。
アール・ストレートを組み合わせることで、自由自在なレイアウトが可能。

 ASO-ST400R(NA)
ASO-ST400R(NA)
ASO-SB900S(MAK)
ASO-SB1200R(MAK)
ASO-SB1200R(MAK)
ASO-SB1200R(MAK)
324












システムベンチ 価格(税抜) サイズ(mm)梱包才数梱包重量
ASO-SB1200R 132,000円 W1200×D565×H3803.2才25kg
仕様/天板:パーティクルボード 抗ウイルスメラミン化粧板(t30mm)ABSエッジ 抗ウイルスABSエッジ(SGRは 通常ABS) 本体:メラミン化粧板 入数:1

システムベンチ 価格(税抜) サイズ(mm)梱包才数梱包重量
ASO-SB900S 99,000円 W900×D450×H3801.9才22kg
仕様/天板:パーティクルボード 抗ウイルスメラミン化粧板(t30mm)ABSエッジ 抗ウイルスABSエッジ(SGRは 通常ABS) 本体:メラミン化粧板 入数:1
セット例
円 楕円 S字
450 900 840 380 380 350 227127 850 850 450 1200 R850 380 350 円 S字 楕円
品番 台数 価格 ASO-SB1200R ×4 132,000円 合計 528,000円 品番 台数 価格 ASO-SB1200R ×5 132,000円 合計 660,000円 品番 台数 価格 ASO-SB1200R ×4 132,000円 ASO-SB900S ×2 99,000円 合計 726,000円 ASO-SB9045 ASO-SB1245
ASO-SB SGR:ストーングレー WH:ホワイト NA:ナチュラル MAK:ミディアムオーク BR:ブラウン ■カラーサンプル
ASO-1200R(MAK) ASO-SB900S(BR) 325 SOCIA チェアデスク・収納パーティションテーブルレセプションロビーエクステリアアクセサリー木工 幼保レンタル・リース
記載台シリーズ






 アクセサリー AS-PF20(BK) P.284 VKD-1250H(NA)
VKDK-1250(NA)
VKD-9050L(NA)
VKD-9050L(NA)
VKDK-1250(NA)
アクセサリー AS-PF20(BK) P.284 VKD-1250H(NA)
VKDK-1250(NA)
VKD-9050L(NA)
VKD-9050L(NA)
VKDK-1250(NA)
326
アクセサリー AS-PF20(BK) P.284
記載台
表面に付着したウイルス・菌を減少させる抗ウイルス・ 抗菌メラミン化粧板・エッジを採用しています。
チェアデスク・収納パーティションテーブルレセプションロビーエクステリアアクセサリー木工

抗ウイルス記載台 (ハイタイプ) 価格(税抜)サイズ(mm)


梱包才数梱包重量
VKD-1250H 250,000円 W1200×D500×H10805.0才 61kg
VKD-9050H 230,000円 W900×D500×H10804.2才 54kg 仕様/天板・棚板:パ-ティクルボ-ド 抗ウイルスメラミン化粧板 抗ウイルスABSエッジ 天板裏:抗ウイルスバッカ- 本体: パ-ティクルボ-ド 抗ウイルスメラミン化粧板 幕板:パ-ティクルボ-ド 抗ウイルスメラミン化粧板 側板:パ-ティクルボ-ド 抗ウイルスメラミン化粧板 用紙スタンド・ペントレ-:アクリル 入数:1(4個口) 天板高:H1000 ●1250H/用紙スタンド 2個・ペントレ-(大)3個付・●9050H/用紙スタンド2個・ペントレ-(大)1個、(小)1個付


抗ウイルス記載台 (ロータイプ) 価格(税抜)サイズ(mm)梱包才数梱包重量
VKD-1250L 230,000円 W1200×D500×H8303.6才 44kg
VKD-9050L 218,000円 W900×D500×H8302.4才 39kg 仕様/天板・棚板:パ-ティクルボ-ド 抗ウイルスメラミン化粧板 抗ウイルスABSエッジ 天板裏:抗ウイルスバッカ- 本体: パ-ティクルボ-ド 抗ウイルスメラミン化粧板 幕板:パ-ティクルボ-ド 抗ウイルスメラミン化粧板 側板:パ-ティクルボ- ド 抗ウイルスメラミン化粧板 用紙スタンド・ペントレ-:アクリル 入数:1(3個口) 天板高:H750 ●1250L/用紙スタ ンド2個・ペントレ-(大)3個付・●9050L/用紙スタンド2個・ペントレ-(大)1個、(小)1個付

抗ウイルス記載台 (掲示板付)




掲示板使用例
価格(税抜)サイズ(mm) 梱包才数梱包重量
VKDK-1250 367,000円 W1200×D500×H16006.5才 78kg
VKDK-9050 304,500円 W900×D500×H16004.9才 65kg 仕様/天板・棚板:パ-ティクルボ-ド 抗ウイルスメラミン化粧板 抗ウイルスABSエッジ 天板裏:抗ウイルスバッカ- 本 体:パ-ティクルボ-ド 抗ウイルスメラミン化粧板 用紙スタンド・ペントレ-・掲示板:アクリル 入数:1250/1(6個口)、 9050/1(5個口) ●1250/用紙スタンド2個・ペントレ- (大) 3個・掲示板2セット付・●9050/用紙スタンド2個・ペントレ- (大) 1個、(小) 1個・掲示板1セット付








紙スタンド内寸 W220XD18XH130 1000 900 242 500 401 1200 207 1080 1080 401 紙スタンド内寸 : W220XD18XH130 750 900 317 500 401 1200 730 830 401 830 紙スタンド内寸 W220XD18XH130 1000 846 900 242 500 401 1146 1200 530 795 450 450 207 1600 1600 401
VKD-9050H(NA)
VKD-9050L(NA)
VKD-1250L(NA)
VKD-1250H(NA)
VKD-9050H・1250H
VKDK-9050・1250
VKD-9050L・1250L
VKDK-1250(NA)
アクリルケース使用例 アクリルケース付属
■天板色 327 SOCIA
NA:ナチュラル
幼保レンタル・リース
ハイカウンターシリーズ

VLCT-1570(NA)
VLCT-KP870(NA)
VHCT-1545(NA)
アクセサリー AS-PF20(BK) P.284
VHCT-1245(NA)
VHCT-C500(NA)
VHCT-845(NA)





 VHCT-845(NA)
VHCT-C500(NA) VHCT-1245(NA)
VLCT-870(NA)
チェア
CK01(BK) P.079
VLCT-C800(NA)
VLCT-1570(NA)
VLCT-KP870(NA)
VHCT-1545(NA)
VKDK-1250
VKD-9050L
VHCT-845(NA)
VHCT-C500(NA) VHCT-1245(NA)
VLCT-870(NA)
チェア
CK01(BK) P.079
VLCT-C800(NA)
VLCT-1570(NA)
VLCT-KP870(NA)
VHCT-1545(NA)
VKDK-1250
VKD-9050L
328

ハイカウンター
チェアデスク・収納パーティションテーブルレセプションロビーエクステリアアクセサリー木工





VHCT-1545
224,000円 W1500×D450×H10006.8才 40kg
VHCT-1245 217,000円 W1200×D450×H10004.9才 39kg
VHCT-845 167,000円 W800×D450×H10003.7才 31kg 仕様/天板:抗ウイルスメラミン化粧板 天板裏:抗ウイルスバッカ- 抗ウイルスABSエッジ パ-ティクルボ-ド ハニカムコア フラッシュ 加工 本体:抗ウイルスメラミン化粧板 パ-ティクルボ-ド ハニカムコア フラッシュ加工 入数:1(3個口)


抗ウイルス

ハイコーナーカウンター 価格(税抜)サイズ(mm) 梱包才数梱包重量
VHCT-C500
164,000円 W500×D500×H10002.5才 32kg 仕様/天板:抗ウイルスメラミン化粧板 天板裏:抗ウイルスバッカ- 抗ウイルスABSエッジ パ-ティクルボ-ド 本体:抗ウイルスメラミン化粧板 パ-ティクルボ-ド ハニカムコア フラッシュ加工 入数:1(2個口)



抗ウイルス レジハイカウンター 価格(税抜)サイズ(mm) 梱包才数梱包重量
VHCT-RS6050 217,000円 W600×D500×H10005.0才 54kg 仕様/天板:抗ウイルスメラミン化粧板 天板裏:抗ウイルスバッカ- 抗ウイルスABSエッジ パ-ティクルボ-ド ハニカムコア フラッシュ 加工 本体:抗ウイルスメラミン化粧板 パ-ティクルボ-ド ハニカムコア フラッシュ加工 入数:1(3個口) 天板高:H850 ●可動棚2枚付


抗ウイルス手荷物台 価格(税抜)サイズ(mm) 梱包才数梱包重量
VTT-440 76,000円 W400×D400×H6000.9才 17kg 仕様/天板:抗ウイルスメラミン化粧板 天板裏:抗ウイルスバッカ- 抗ウイルスABSエッジ パ-ティクルボ-ド 本体:抗ウイルスメラミン化粧板 パ-ティクルボ-ド 入数:1
幼保レンタル・リース





1000 205196 1446/1146/746 1500/1200/800 450 230 430 450 R500 500 500 450 1000 230 1000 850 160162 550 600 500 引出し内寸: W496XD343XH105 160 471 350 400 600 550 400 396
価格(税抜)サイズ(mm) 梱包才数梱包重量
抗ウイルスハイカウンター
VHCT-845(NA)
VHCT-C500(NA)
VHCT-1245(NA)
VHCT-1545(NA)
カウンター内側
VHCT-845・1245・1545
VHCT-C500
VHCT-RS6050
VHCT-RS6050(NA) レジ台(引き出し)
レジ台(配線ホール)
VTT-440(NA)
手荷物台(使用例)
VTT-440
■天板色 329 SOCIA
NA:ナチュラル
ローカウンターシリーズ






 VLCT-870(NA)
VLCT-C800(NA)
VLCT-1570(NA)
VLCT-KP870(NA)
VLCT-870(NA)
VLCT-C800(NA)
VLCT-1570(NA)
VLCT-KP870(NA)
VHCT-1545(NA)
VHCT-845(NA)
VHCT-C500(NA)
VHCT-1245(NA)
VLCT-870(NA)
VLCT-C800(NA)
VLCT-1570(NA)
VLCT-KP870(NA)
VLCT-870(NA)
VLCT-C800(NA)
VLCT-1570(NA)
VLCT-KP870(NA)
VHCT-1545(NA)
VHCT-845(NA)
VHCT-C500(NA)
VHCT-1245(NA)
330
アクセサリー AS-PF20(BK) P.284
ローカウンター
チェアデスク・収納パーティションテーブルレセプションロビーエクステリアアクセサリー木工




抗ウイルスローカウンター 価格(税抜)サイズ(mm) 梱包才数梱包重量
VLCT-1570
VLCT-1270
242,000円 W1500×D700×H7204.1才 34kg
233,000円 W1200×D700×H7203.6才 30kg
VLCT-870 184,000円 W800×D700×H7202.8才 25kg 仕様/天板:抗ウイルスメラミン化粧板 天板裏:抗ウイルスバッカ- 抗ウイルスABSエッジ パ-ティクルボ-ド ハニカムコア フラッシュ 加工 本体:抗ウイルスメラミン化粧板 パ-ティクルボ-ド ハニカムコア フラッシュ加工 入数:1(2個口)

抗ウイルス ローコーナーカウンター
VLCT-C800

価格(税抜)サイズ(mm) 梱包才数梱包重量
182,000円 W800×D800×H7203.0才 28kg 仕様/天板:抗ウイルスメラミン化粧板 天板裏:抗ウイルスバッカ- 抗ウイルスABSエッジ パ-ティクルボ-ド ハニカムコア フラッシュ 加工 本体:抗ウイルスメラミン化粧板 パ-ティクルボ-ド ハニカムコア フラッシュ加工 入数:1(2個口)


抗ウイルスローカウンター (片面パネル) 価格(税抜)サイズ(mm) 梱包才数梱包重量
VLCT-KP1270
VLCT-KP870
250,000円 W1200×D705×H12004.5才 35kg
199,000円 W800×D705×H12003.8才 30kg 仕様/天板:抗ウイルスメラミン化粧板 天板裏:抗ウイルスバッカ- 抗ウイルスABSエッジ パ-ティクルボ-ド ハニカムコア フラッシュ 加工 本体:抗ウイルスメラミン化粧板 パ-ティクルボ-ド ハニカムコア フラッシュ加工 入数:1(2個口) ●天板高:H720


抗ウイルスローカウンター (両面パネル) 価格(税抜)サイズ(mm) 梱包才数梱包重量
VLCT-RP1270
265,000円 W1200×D705×H12004.5才 38kg
VLCT-RP870 218,000円 W800×D705×H12003.7才 34kg 仕様/天板:抗ウイルスメラミン化粧板 天板裏:抗ウイルスバッカ- 抗ウイルスABSエッジ パ-ティクルボ-ド ハニカムコア フラッシュ 加工 本体:抗ウイルスメラミン化粧板 パ-ティクルボ-ド ハニカムコア フラッシュ加工 入数:1(2個口) ●天板高:H720





720 695 1446/1146/746 1500/1200/800 700 720 695 700 R800 800 800 700 700 720 695 1200 705 1200/800 1175/775 1148/748 700 720 480 695 1200 705 1150/750 1200/800
VLCT-870(NA)
VLCT-1270(NA)
VLCT-1570(NA)
VLCT-870・1270・1570
VLCT-C800
VLCT-RP870・RP1270
VLCT-KP870・KP1270
VLCT-C800(NA)
VLCT-KP870(NA)
VLCT-KP1270(NA)
VLCT-RP870(NA)
VLCT-RP1270(NA)
■天板色 331 SOCIA
NA:ナチュラル
幼保レンタル・リース

VCH-UK+VCH-UKZ+VCH-ARW×2

VCH-RC+VCH-SOZ+VCH-AR+VCH-ARW
受付カウンターシリーズ

抗ウイルス
価格(税抜)サイズ(mm)梱包才数梱包重量
VCH-UK 335,000円 W900×D750×H15007.5才81.6kg
仕様/本体:抗ウイルスメラミン化粧板 (t26mm) 抗ウイルスABSエッジ 入数:1(5個口)

抗ウイルス デスクカウンター 価格(税抜)サイズ(mm)梱包才数梱包重量
VCH-DE 323,000円 W900×D750×H15007.5才81.5kg
仕様/本体:抗ウイルスメラミン化粧板 (t26mm) 抗ウイルスABSエッジ 入数:1(5個口)
■カラーサンプル


NA:ナチュラル







WH:ホワイト BR:ブラウン
MAK:ミディアムオーク

抗ウイルス 受付カウンター増結セット 価格(税抜)サイズ(mm)梱包才数梱包重量 VCH-UKZ 282,000円 W875×D750×H15005.3才64.1kg
仕様/本体:抗ウイルスメラミン化粧板 (t26mm) 抗ウイルスABSエッジ 入数:1(4個口)

抗ウイルス デスクカウンター増結セット 価格(税抜)サイズ(mm)梱包才数梱包重量
VCH-DEZ 282,000円 W875×D750×H15005.3才64.1kg
仕様/本体:抗ウイルスメラミン化粧板 (t26mm) 抗ウイルスABSエッジ 入数:1(4個口)
1000 900 848 700 750 1120 730 1 80 500 150 874 VCH-DE VCH-DEZ 1000 900 848 700 750 1120 730 1 80 500 150 874 VCH-DE VCH-DEZ 1120 900 848 750 1000 700 844130 550 500 150 874 VCH-UK VCH-UKZ 1120 900 848 750 1000 700 844130 550 500 150 874 VCH-UK
VCH-UKZ
受付カウンター
VCH-UK
VCH-UK
VCH-UKZ
VCH-UKZ
VCH-DE VCH-DE VCH-DEZ VCH-DEZ
332
受付カウンターシリーズ
チェアデスク・収納パーティションテーブルレセプションロビーエクステリアアクセサリー木工

抗ウイルス 相談カウンター 価格(税抜)サイズ(mm)梱包才数梱包重量
VCH-SO 294,000円 W900×D750×H15006.7才67.4kg
仕様/本体:抗ウイルスメラミン化粧板 (t26mm) 抗ウイルスABSエッジ 入数:1(5個口)

抗ウイルス レジカウンター 価格(税抜)サイズ(mm)梱包才数梱包重量
VCH-RC 291,000円 W650×D750×H15006.8才66.4kg
仕様/本体:抗ウイルスメラミン化粧板 (t26mm) 抗ウイルスABSエッジ 入数:1(5個口)

抗ウイルス 飛沫ガードワイドパネル 価格(税抜)サイズ(mm)梱包才数梱包重量
VCH-ARW 45,000円 W864×D150×H7000.6才7.4kg
仕様/パネル:アクリル樹脂 (t5.0mm) 脚:スチ-ル 粉体塗装 入数:1(2個口)

抗ウイルス 相談カウンター増結セット 価格(税抜)サイズ(mm)梱包才数梱包重量
VCH-SOZ 238,000円 W875×D750×H15004.5才50kg
仕様/本体:抗ウイルスメラミン化粧板 (t26mm) 抗ウイルスABSエッジ 入数:1(4個口)

抗ウイルス レジカウンター増結セット 価格(税抜)サイズ(mm)梱包才数梱包重量
VCH-RCZ 238,000円 W625×D675×H15004.5才49kg
仕様/本体:抗ウイルスメラミン化粧板 (t26mm) 抗ウイルスABSエッジ 入数:1(4個口)

幼保レンタル・リース
抗ウイルス 飛沫ガードパネル 価格(税抜)サイズ(mm)梱包才数梱包重量
VCH-AR 33,000円 W594×D150×H7000.5才6.5kg
仕様/パネル:アクリル樹脂 (t5.0mm) 脚:スチ-ル 粉体塗装 入数:1(2個口)
500 846 5 150 150 VCH-ARW VCH-AR 700 360 594 5 150 150 700 500 846 5 150 150 VCH-ARW VCH-AR 700 360 594 5 150 150 700 1120 1000 650 598 700 750 1 30 500 150 624 VCH-RC VCH-RCZ 730 1120 1000 650 598 700 750 1 30 500 150 624 VCH-RC VCH-RCZ 730 900 848 730 750 600 307 267 874 VCH-SO VCH-SOZ 1120 1 45 900 848 730 750 600 307 267 874 VCH-SO VCH-SOZ 1120 1 45
VCH-SO
VCH-SO
VCH-SOZ
VCH-SOZ
VCH-RC
VCH-RC
VCH-RCZ
VCH-RCZ
VCH-ARW
VCH-ARW
VCH-AR
333 SOCIA
VCH-AR
VWLTシリーズ
利用者に特化した介助しやすい対面型昇降式テーブル
コンパクトサイズで自由な配置が可能です。
テーブルの高さは、10段階調節が出来て多種の肘付き椅子に対応しています。
キャスター仕様は、移動も楽々。介助者の負担も軽減します。
天板は、表面・エッジから裏面まで安心の抗ウイルス仕様です。
三つの形状をラインナップ、自由な配置でベストな介助に対応 利用者専用のテーブルであり
食事介助しやすいテーブル形状。

介助者
利用者
少し奥まで入れるテーブル形状が介助を手助け


334
レンタル・リース
Welfare Kindergarten
Rental / Lease
食事・多目的ルーム向けテーブル 抗ウイルス 昇降式テーブル
VWLTシリーズ(車いす対応)
チェアデスク・収納パーティションテーブルレセプションロビーエクステリアアクセサリー木工
機能詳細

● 3
● 4
● 1
● 2
● 2
アジャスター仕様



● 2
VWLT-1010(NA)
アジャスター 2個キャスター 2個仕様

● 3

3
●
キャスター仕様




抗ウイルスソフトエッジ NA:ナチュラル ■カラーサンプル

● 1 高さ調節機能


10段階(20㎜ピッチ)目盛付き(600~800㎜)天板を持ち 上げるだけの簡単操作で高さ調節することができます。(最大 限まで上げて解除)

● 2 ● 3 アジャスター・キャスター
付け替えや微調整が可能です。 (10㎜まで)
● 2 ● 3
※キャスターはストッパー付き
全面抗ウイルス・抗菌仕様天板 ● 4

手を触れる表面・縁材(自社開発ソフトエッジ) ・裏面すべて抗ウイルス・抗菌処理を施しています。
抗ウイルス昇降式 テーブル 価格(税抜) サイズ(mm)梱包才数梱包重量
VWLT-1010 154,000円 W1010×D910×H600~8002.4才18kg
VWLT-9060 145,000円 W900×D600×H600~8001.9才17.5kg
VWLT-9090 146,000円 W900×D900×H600~8002.3才21.5kg
仕様/天板:抗ウイルスメラミン化粧板 (t28mm) 抗ウイルスソフトエッジ 天板裏:抗ウイルスバッカ- 脚:スチ-ル (φ60.5mm) 木目シ-ト貼り (ナチュラル) 入数:1(2個口) ●H600~800mmまで10段 階 (20mmピッチ) の高さ調節が可能です。 ●アジャスタ-を回転させて10mmまで高さ調節可能です。
●天板を持ち上げるだけの簡単操作で高さ調節することができます。 (最大限まで上げて解除)
抗ウイルス昇降式テーブル (片脚キャスター脚) 価格(税抜) サイズ(mm)梱包才数梱包重量
VWLT-K9060 145,000円 W900×D600×H600~8001.9才17.5kg
VWLT-K9090 146,000円 W900×D900×H600~8002.3才21.5kg
仕様/天板:抗ウイルスメラミン化粧板 (t28mm) 抗ウイルスソフトエッジ 天板裏:抗ウイルスバッカ- 脚:スチ-ル (φ60.5mm) 木目シ-ト貼り (ナチュラル) 入数:1(2個口) ●H600~800mmまで10段 階 (20mmピッチ) の高さ調節が可能です。 ●アジャスタ-を回転させて10mmまで高さ調節可能です。 ●天板を持ち上げるだけの簡単操作で高さ調節することができます。 (最大限まで上げて解除)
●テ-ブル脚の片側2本はキャスタ-仕様
抗ウイルス昇降式テーブル (キャスター脚) 価格(税抜) サイズ(mm)梱包才数梱包重量
幼保レンタル・リース
VWLT-W1010 154,000円 W1010×D910×H600~8002.4才18kg
VWLT-W9060 145,000円 W900×D600×H600~8001.9才17.5kg
VWLT-W9090 146,000円 W900×D900×H600~8002.3才21.5kg
仕様/天板:抗ウイルスメラミン化粧板 (t28mm) 抗ウイルスソフトエッジ 天板裏:抗ウイルスバッカ- 脚:スチ-ル (φ60.5mm) 木目シ-ト貼り (ナチュラル) 入数:1(2個口) ●H600~800mmまで10段 階 (20mmピッチ) の高さ調節が可能です。 ●キャスター仕様
●天板を持ち上げるだけの簡単操作で高さ調節することができます。 (最大限まで上げて解除)
VWLT-K9090(NA)
VWLT-K9090(NA)
VWLT-W1010(NA)
VWLT-W9090(NA)
VWLT-W9060(NA)
VWLT-K9060(NA)
VWLT-9090(NA)
VWLT-9060(NA)
335 SOCIA
抗ウイルス 昇降式テーブル
VMRTシリーズ(車いす対応)
機能詳細
● 4
食事・多目的ルーム向けテーブル 抗ウイルスソフトエッジ DBR:ダークブラウン NA:ナチュラル ■カラーサンプル





● 2
VMRT-K1890(DBR)
● 2 アジャスター仕様


● 1
● 1 高さ調節機能

10段階(20㎜ピッチ)目盛付き(600~800㎜)天 板を持ち上げるだけの簡単操作で高さ調節すること ができます。(最大限まで上げて解除)

● 3


● 2 ● 3 アジャスター 2個キャスター 2個仕様

● 3 キャスター仕様


● 2 ● 3 アジャスター・キャスター
● 2 ● 3

付け替えや微調整が可能です。 (10㎜まで) ※キャスターはストッパー付き
全面抗ウイルス・抗菌仕様天板 ● 4
手を触れる表面・縁材(自社開発ソフトエッジ) ・裏面すべて抗ウイルス・抗菌処理を施しています。
抗ウイルス昇降式 テーブル 価格(税抜)サイズ(mm)梱包才数梱包重量
VMRT-1690 174,000円 W1600×D900×H600~800 3.0才28.5kg
VMRT-1890 175,000円 W1800×D900×H600~800 ▲ 3.2才30.5kg 仕様/天板:抗ウイルスメラミン化粧板 (t28mm) 抗ウイルスソフトエッジ 天板裏:抗ウイルスバッカ- 脚:スチ-ル (φ60.5mm) 木目シ-ト貼り (ダ-クブラウン)・脚:スチ-ル (φ60.5mm) 木目シ-ト貼り (ナチュラル) 入数:1(2個口) ●H600~800mmまで10段階 (20mmピッチ) の高さ調節が可能です。 ●アジャスタ-を回転させて10mmまで高さ 調節可能です。 ●天板を持ち上げるだけの簡単操作で高さ調節することができます。 (最大限まで上げて解除)
VMRT-1690・VMRT-1890
抗ウイルス昇降式テーブル (片脚キャスター脚) 価格(税抜)サイズ(mm)梱包才数梱包重量
VMRT-K1690 174,000円 W1600×D900×H600~800 3.0才28.5kg
VMRT-K1890 175,000円 W1800×D900×H600~800 ▲ 3.2才30.5kg 仕様/天板:抗ウイルスメラミン化粧板 (t28mm) 抗ウイルスソフトエッジ 天板裏:抗ウイルスバッカ- 脚:スチ-ル (φ60.5mm) 木目シ-ト貼り (ダ-クブラウン)・脚:スチ-ル (φ60.5mm) 木目シ-ト貼り (ナチュラル) 入数:1(2個口) ●H600~800mm まで10段階 (20mmピッチ) の高さ調節が可能です。 ●アジャスタ-を回転させて10mmまで高さ調節可能です。 ●天板を持 ち上げるだけの簡単操作で高さ調節することができます。 (最大限まで上げて解除) ●テ-ブル脚の片側2本はキャスタ-仕様 抗ウイルス昇降式テーブル (キャスター脚) 価格(税抜)サイズ(mm)梱包才数梱包重量
VMRT-K1690・VMRT-K1890
VMRT-W1690 174,000円 W1600×D900×H600~800 3.0才28.5kg
VMRT-W1890 175,000円 W1800×D900×H600~800 ▲ 3.2才30.5kg 仕様/天板:抗ウイルスメラミン化粧板 (t28mm) 抗ウイルスソフトエッジ 天板裏:抗ウイルスバッカ- 脚:スチ-ル (φ60.5mm) 木目シ-ト貼り (ダ-クブラウン)・脚:スチ-ル (φ60.5mm) 木目シ-ト貼り (ナチュラル) 入数:1(2個 口) ●H600~800mmまで10段階 (20mmピッチ) の高さ調節が可能です。 ●キャスター仕様 ●天板を持ち 上げるだけの簡単操作で高さ調節することができます。 (最大限まで上げて解除)
VMRT-W1690・VMRT-W1890
1800/ 1600 1510/ 1310 600 ~ 800 570~770 610 900 20 mm ピッチ 1800/ 1600 1524/ 1324 600 ~ 800 570~770 610 900 20 mm ピッチ 1800/ 1600 1539/ 1339 600 ~ 800 570~770 639 900 20 mm ピッチ
VMRT-1890(NA)
VMRT-1890(DBR)
VMRT-K1890(NA)
VMRT-K1890(DBR)
VMRT-W1890(NA)
336
VMRT-W1890(DBR)
抗ウイルス ハイアジャスターテーブル
VHAJ/VHAK/VHAC(車いす対応)
チェアデスク・収納パーティションテーブルレセプションロビーエクステリアアクセサリー木工

機能詳細 ● 1 ● 2 ● 3

VHAK-K1290
※VHAK
● 1
食事・多目的ルーム向けテーブル

抗ウイルスソフトエッジ NA:ナチュラル ■カラーサンプル

● 1 ハイアジャスター



アジャスターを回転させて高さ50㎜ま で無段階に調節することができます。
VHAJ・VHAK
● 2 リフトロックキャスター
ロックをすると支柱が下降、接 地します。
車輪を浮かすことにより脚を 固定します。
VHAK・VHAC
● 3 全面抗ウイルス・抗菌仕様天板
手を触れる表面・縁材(自社開発ソフトエッジ) ・裏面すべて抗ウイルス・抗菌処理を施しています。
片側キャスター仕様なので、女性でも簡単に テーブルの移動が可能です。

VHAJ-K1690 VHAJ-K
● 1
ハイアジャスター 2個

VHAK-K1290
VHAJ VHAK VHAC ハイアジャスター 4個
● 2
● 2
抗ウイルスハイアジャスター テーブル 価格(税抜)サイズ(mm)梱包才数梱包重量
VHAJ-K1290
VHAJ-K1590
VHAJ-K1690
VHAJ-K1890
119,000円 W1200×D900×H700~750 1.8才15kg
122,000円 W1500×D900×H700~750 2.1才19kg
124,000円 W1600×D900×H700~750 2.2才20kg
125,000円 W1800×D900×H700~750 ▲ 2.4才21kg
仕様/天板:抗ウイルスメラミン化粧板 (t28mm) 抗ウイルスソフトエッジ 天板裏:抗ウイルスバッカ- 脚:スチ-ル (φ50.8mm) 樹脂カバ-付 入数:1(2個口) ●アジャスタ-を回転させて50mmまで高さ 調節が可能です。
リフトアップキャスター 2個
抗ウイルスハイアジャスター テーブル (片脚キャスター脚) 価格(税抜)サイズ(mm)梱包才数梱包重量
VHAK-K1290
VHAK-K1590
VHAK-K1690
VHAK-K1890
リフトアップキャスター 4個

VHAK-K
VHAC-1590 VHAC
128,000円 W1200×D900×H700~750 1.8才15kg
130,000円 W1500×D900×H700~750 2.1才19kg
132,000円 W1600×D900×H700~750 2.2才20kg
133,000円 W1800×D900×H700~750 ▲ 2.4才21kg
仕様/天板:抗ウイルスメラミン化粧板 (t28mm) 抗ウイルスソフトエッジ 天板裏:抗ウイルスバッカ- 脚:スチ-ル (φ50.8mm) 樹脂カバ-付 入数:1(2個口) ●アジャスタ-を回転させて50mmまで高さ 調節が可能です。 ●テ-ブル脚の片側2本はリフトロックキャスタ-仕様
VHAJ-K1890/K1690
抗ウイルスハイアジャスター テーブル (キャスター脚) 価格(税抜)サイズ(mm)梱包才数梱包重量
VHAC-1290
VHAC-1590
VHAC-1690
VHAC-1890
幼保レンタル・リース
137,000円 W1200×D900×H700~750 1.8才15kg
139,000円 W1500×D900×H700~750 2.1才19kg
141,000円 W1600×D900×H700~750 2.2才20kg
142,000円 W1800×D900×H700~750 ▲ 2.4才21kg
仕様/天板:抗ウイルスメラミン化粧板 (t28mm) 抗ウイルスソフトエッジ 天板裏:抗ウイルスバッカ- 脚:スチ-ル (φ50.8mm) 樹脂カバ-付 入数:1(2個口) ●アジャスタ-を回転させて50mmまで高さ 調節が可能です。 ●テ-ブル脚の4本すべてがリフトロックキャスタ-仕様
中野 2019.8.8 中野 2021.8.2 製図 訂正 抗ウィルス ハイアジャスタ テ ブル
655 1555/ 1355/ 1255/ 955 700 750 900 1800/1600/ 1500/ 1200 672 722 X 0.015 中野 2019.8.8 中野 2021.8.2 X 0.015 抗ウィルスハイアジャスターテーブル (片側キャスター脚)
K1590/K1290
655 1555/ 1355/ 1255/ 955 700 ~ 750 900 1800/ 1600/ 1500/ 1200 672 ~ 722 655 1555/ 1355/ 1255/ 955 700 750 900 1800/1600/ 1500/ 1200 672 722 700~750mm 1600mm 900mm 900mm 700~750mm 1200mm 900mm 1500mm 700~750mm
VHAK-K1890/K1690 K1590/K1290
337 SOCIA
抗ウイルス 福祉用テーブル
VFTR
機能詳細

● 1

食事・多目的ルーム向けテーブル
■カラーサンプル

抗ウイルスソフトエッジ NA:ナチュラル

● 1 全面抗ウイルス・抗菌仕様天板
手を触れる表面・縁材(自社開発ソフトエッジ) ・裏面すべて抗ウイルス・抗菌処理を施しています。

仕様/天板:抗ウイルスメラミン化粧板 (t28mm) 抗ウイルスソフトエッジ 天板裏:抗ウイルスバッカ- 脚:スチ-ル (φ 50.8mm) 粉体塗装 入数:1
700 672 1600/ 1400/ 1300/ 1000 1800/ 1600/ 1500/ 1200 900 700 900mm 1800mm 700mm 抗ウイルス福祉用 テーブル 価格(税抜)サイズ(mm)梱包才数梱包重量 VFTR-1290N 105,000円 W1200×D900×H7004.3才 15kg VFTR-1590N 106,000円 W1500×D900×H7005.3才 17kg VFTR-1690N 107,000円 W1600×D900×H700 ▲ 5.5才 20kg VFTR-1890N 108,000円 W1800×D900×H700 ▲ 6.2才 23kg
VFTR-1890N(NA)
VFTR-1890N(NA)
VFTR-1590N(NA)
VFTR
338
抗ウイルス 跳ね上げ式昇降テーブル
VRK
食事・多目的ルーム向けテーブル
機能詳細
● 3
● 1

VRK-F1890 (昇降式)
天板跳ね上げ機能 ● 1


● 2

跳ね上げイメージ跳ね上げ時 天板下のレバー操作で天板を跳ね上 げることができ、収納スペースをとりま せん。

ロック解除時 ロック時 ロックをすると支柱が降りて、車輪部が浮くことでキャスターの 動きを止めるリフトロックキャスターを採用。

抗ウイルスソフトエッジ NA:ナチュラル ■カラーサンプル

高さ調節機能

7段階(20㎜ピッチ) 目盛付き(660~800㎜)
天板を持ち上げるだけの簡単操作で高さ調節することが できます。(最大限まで上げて解除)
脚部を足で押さえて、天板を持ちあげます。最上部まで上がる とロックが外れ、天板を下げることができます。製品の不具合 を防止するため、天板の昇降を行う際は必ず2名で行い、両 端の脚を同時に操作して下さい。
リフトロックキャスター ● 2 全面抗ウイルス・抗菌仕様天板 ● 3
手を触れる表面・縁材(自社開発ソフトエッジ) ・裏面すべて抗ウイルス・抗菌処理を施しています。
抗ウイルス跳ね上げ式昇降機能付テーブル(車いす対応)


(t28mm) 抗ウイルスソフトエッジ 天板裏:抗ウイルスバッカ- 脚:スチ-ル 粉体塗装 (ナチュラル) 入数:1 ●H660~800mmまで7段階 (20mmピッチ) の高さ調節が可能です。 ●リフト ロックキャスタ-仕様 ●跳ね上げ時:H1115~1255mm
VRK-F
810 660 ~ 800 1610/ 1410 1800/ 1600 900 11 15 ~ 1255 810143 452 ~ 592 跳ね上げ/スタッキング 900mm 1800mm 660 ~ 800mm 抗ウイルス跳ね上げ式 昇降機能付テーブル 価格(税抜) サイズ(mm)梱包才数梱包重量 VRK-F1690 194,000円 W1600×D900×H660~800 ▲ 8.5才 ▲ 34kg VRK-F1890 205,000円 W1800×D900×H660~800 ▲ 9.5才 ▲ 40kg 仕様/天板:抗ウイルスメラミン化粧板
● ※
● ※
VRK-F1890
339 SOCIA
幼保レンタル・リース
VRK-F1690
チェアデスク・収納パーティションテーブルレセプションロビーエクステリアアクセサリー木工
跳ね上げ式テーブル
VTMシリーズ・TMシリーズ
機能詳細
● 1
食事・多目的ルーム向けテーブル
● ※
● 2

天板跳ね上げ機能 ● 1 リフトロックキャスター ● 2 全面抗ウイルス・抗菌仕様天板 (VTMのみ)



跳ね上げイメージ 跳ね上げ時 天板下のレバー操作で天板を跳ね上 げることができ、収納スペースをとりま せん。



ロック解除時 ロック時 ロックをすると支柱が降りて、車輪部が浮くことでキャスターの 動きを止めるリフトロックキャスターを採用。
● ※
手を触れる表面・縁材(自社開発ソフトエッジ) ・裏面すべて抗ウイルス・抗菌処理を施しています。
抗ウイルス跳ね上げ式テーブル

抗ウイルス跳ね上げ 式テーブル 価格(税抜)サイズ(mm)梱包才数梱包重量
VTM-1690 137,000円 W1600×D900×H7009.8才31kg
VTM-1890 139,000円 W1800×D900×H700 ▲ 10.0才36kg
仕様/天板:抗ウイルスメラミン化粧板 (t28mm) 抗ウイルスソフトエッジ 天板裏:抗ウイルスバッカ- 脚:スチ-ル (〼45mm) 粉体塗装 入数:1(2個口) 脚間内寸:W1490×D790・脚間内寸:W1690 ×D790 ●リフトロックキャスタ-仕様 ●跳ね上げ時:H1147mm


跳ね上げ式テーブル 価格(税抜)サイズ(mm)梱包才数梱包重量
TM-1690 129,000円 W1600×D900×H7009.8才31kg
TM-1890 133,000円 W1800×D900×H700 ▲ 10.0才36kg 仕様/天板:メラミン化粧板 (t28mm) ソフトエッジ 脚:スチ-ル (〼45mm) 粉体塗装 入数:1(2個口) 脚間内寸:W1490×D790・脚間内寸:W1690×D790 ●抗菌加工天板使用 ●リフトロックキャスタ- 仕様 ●跳ね上げ時:H1147mm
跳ね上げ/スタッキング 790 700 1487 1600 900 1147 790 138 582 跳ね上げ/スタッキング 790 700 1687 1800 900 1147 790 138 582 900mm 1800mm 700mm
VTM ■カラーサンプル
TM ■カラーサンプル
VTM-1890 抗ウイルスソフトエッジ NA:ナチュラル
NA:ナチュラル
VTM/TM-1690 VTM/TM-1890
340
VTM-1690
TM-1890
抗ウイルス 昇降式テーブル
VWST
チェアデスク・収納パーティションテーブルレセプションロビーエクステリアアクセサリー木工
機能詳細
● 5
● 2

天板高さ調整機能 ● 2

天板の高さが3段階(650・710・ 770)で調節することが可能です。 車椅子を御利用の方にもお使いいた だけます。
天板跳ね上げ機能 ● 3 ● 3
食事・多目的ルーム向けテーブル
■カラーサンプル
NA:ナチュラル


天板のくぼみ(仮) ● 1

天板の特殊形状により、車椅子での食事も 容易です。
リフトロックキャスター ● 4 ● 4 全面抗ウイルス・抗菌仕様天板 ● 5
手を触れる表面・縁材(自社開発ソフトエッジ) ・裏面すべて抗ウイルス・抗菌処理を施しています。


天板下のレバー操作で、天板を跳ね 上げることができ、省スペース収納が 可能です。


ロック 解除時 ロック時 リフトロックキャスター ロックをすると支柱が降りて、車輪部が浮くことでキャスター の動きを止めるリフトロックキャスターを採用。


抗ウイルス昇降式
VWST-9055 147,000円 W900×D555×H650/710/77014.2才 17.5kg 仕様/天板:抗ウイルスメラミン化粧板 (t28mm) 抗ウイルスソフトエッジ 天板裏:抗ウイルスバッカ- 脚:スチ-ル 粉体塗装 (ナチュ ラル) 入数:1 ●リフトロックキャスタ-仕様 ●3段階高さ調節可能
560 876 65 0・ 71 0・ 770 42 0・ 48 0・ 540 103 0・ 109 0・ 1150 59 3・ 65 3・ 713 900 460 555 450150 565 565 290 跳ね上げ/スタッキング
900mm
555mm
650・710・770mm
テーブル
価格(税抜) サイズ(mm) 梱包才数梱包重量
VWST-9055
VWST-9055
VWST-9055 内側
VWST-9055
● 1
341 SOCIA
幼保レンタル・リース
抗ウイルス Cafeテーブル
ASO-CFシリーズ 手を触れる表面・縁材(ABSエッジ)・裏面すべて抗ウイルス・ 抗菌処理を施しています。
機能詳細


談話室・多目的ルーム With コロナ対策推奨製品 3 1 2 3 1 2 3 1 2
安心の抗ウイルス天板
表面材 抗ウイルス・抗菌メラミン化粧板 縁材 抗ウイルス・抗菌ABSエッジ


ASO-CF750(丸天板タイプ)



■カラーサンプル






裏面 抗ウイルス・抗菌バッカー 脚フレームはマットブラック塗装と ホワイト塗装からお選びいただけます。



カフェテーブル 価格(税抜)サイズ(mm)梱包才数梱包重量
ASO-CF750B 64,000円 φ750×H7203.7才11kg
ASO-CF750W 64,000円 φ750×H7203.7才11kg
仕様/天板:抗ウイルスメラミン化粧板 (t20mm) 抗ウイルスABSエッジ(SGRは通常ABS) 天板裏:抗ウイルスバッカ- 芯材:パ-ティクルボ-ド 脚:スチール 粉体塗装(B・ブラック、W・ホワイト) 入数:1(2個口)
ASO-CF7575(角天板タイプ)




カフェテーブル 価格(税抜)サイズ(mm)梱包才数梱包重量
ASO-CF7575B 69,000円 W750×D750×H7203.7才13kg
ASO-CF7575W 69,000円 W750×D750×H7203.7才13kg 仕様/天板:抗ウイルスメラミン化粧板 (t20mm) 抗ウイルスABSエッジ(SGRは通常ABS) 天板裏:抗ウイルスバッカ- 芯材:パ-ティクルボ-ド 脚:スチール 粉体塗装(B・ブラック、W・ホワイト) 入数:1(2個口)
520 720 Φ750 520 720 □750 750mm 750mm 750mm 720mm 720mm
ASO-CF750W (NA)
ASO-CF7575B (WH)
ASO-CF750B(MAK)
ASO-CF750B(WH)
ASO-CF750W(NA)
ASO-CF750W(BR)
ASO-CF7575B(NA)
ASO-CF7575B(BR)
ASO-CF7575W(MAK)
ASO-CF7575W(WH)
SGR:ストーングレー NA:ナチュラル WH:ホワイト MAK:ミディアムオーク BR:ブラウン
ASO-CF7575B/W 342
ASO-CF750B/W
木製チェア
MC-620
多機能レザー張りモデル
チェアデスク・収納パーティションテーブルレセプションロビーエクステリアアクセサリー木工
機能詳細
● 4

● 1
体圧分散 (モールドウレタン) ● 1

食事・多目的ルーム向けチェア
ウェービングテープ構造 ● 2
● 4 ● 3 ● 3
● 2
座面クッションは適度な固さのあるモールドウレタ ンを採用することにより、着座時の安定性が向上 して体圧分散と姿勢保持を両立しています。
● 3
耐アルコールなど多機能レザー貼り


ウェービングテープ構造 合板構造(従来品)
MCは通常の合板構造とは異なりウェービング テープを使用することでクッション性に優れた座り 心地を実現しています。
コンパクト設計
ワイド寸法を510㎜に抑えることで身体か収まり やすくホールド感も向上しています。
※完成品出荷対応可能。お気軽にお問い合わせください。
木製(ナチュラル色・ブラウン色) 多機能レザー仕様








■カラーサンプル


IV:アイボリー

LGN:ライトグリーン




幼保レンタル・リース
木製チェア 価格(税抜) サイズ(mm) 梱包才数梱包重量
MC-620BR 32,000円 W510×D560×H775 (SH410)4.7才 16kg
MC-620NA 32,000円 W510×D560×H775 (SH410)4.7才 16kg 仕様/張地:合成皮革 (ポリ塩化ビニ-ル) 座:モールドウレタン+ウェービングテープ+MDF フレ-ム:成型合板 粉体塗装 入数:2 ●スタッキング可能 (4脚まで)
座った状態で椅子を引きずらないで下さい。ボルトが緩む恐れがあります。
MC-620NA・BR
560mm 775mm 510mm 410mm 775 560 1070 680 510 446 (座) 455 41 0 61 0 スタッキング/ 4脚
MC-620NA(BJ)
MC-620BR(BJ)
MC-620NA(GN)
MC-620BR(PK)
MC-620NA(OR)
MC-620BR(OR)
MC-620-NA(BJ)
OR:オレンジ GN:グリーン BJ:ベージュ
BL:ブルー PK:ピンク
MC-620NA(BJ)
343 SOCIA
木製チェア
MC-840
豊富なカラーが選べる機能レザー張りモデル
機能詳細
4

3
● 1
体圧分散 (モールドウレタン) ● 1

座面クッションは適度な固さのあるモールドウレタ ンを採用することにより、着座時の安定性が向上 して体圧分散と姿勢保持を両立しています。
耐アルコールなど多機能レザー貼り ● 3
食事・多目的ルーム向けチェア
ウェービングテープ構造 ● 2


ウェービングテープ構造 合板構造(従来品)
MCは通常の合板構造とは異なりウェービング テープを使用することでクッション性に優れた座り 心地を実現しています。
コンパクト設計 ● 4
ワイド寸法を510㎜に抑えることで身体が収まり やすくホールド感も向上しています。
※完成品出荷対応可能。お気軽にお問い合わせください。
木製(ナチュラル色・ブラウン色) 多機能レザー仕様

410mm

560mm 775mm 510mm




■カラーサンプル































木製チェア 価格(税抜) サイズ(mm) 梱包才数梱包重量 MC-840BR 30,000円 W510×D560×H775 (SH410)4.7才16kg MC-840NA 30,000円 W510×D560×H775 (SH410)4.7才16kg 仕様/張地:合成皮革 (ポリ塩化ビニ-ル) 座:モールドウレタン+ウェービングテープ+MDF フレ-ム:成型合板 粉体塗装 入数:2 ●スタッキング可能 (4脚まで)




座った状態で椅子を引きずらないで下さい。ボルトが緩む恐れがあります。
MC-840NA(MD17)
MC-840BR(MD90)
MC-840NA(MD77)
MC-840BR(MD80)
MC-840NA(MD84)
MC-840BR(MD48)
MC-840BR(MD79)
●
●
●
●
3
2
MD89 MD88 MD91 MD90
MC-840NA/BR 中野 製図 訂正 品名 図番 木製チェア 775 560 1070 680 510 446 (座) 455 41 0 61 0 X 0.015 スタッキング/ 4脚 MC-840NA/MC-840BR
344
木製チェア
MC-510
リーズナブルな汎用レザー張りモデル
チェアデスク・収納パーティションテーブルレセプションロビーエクステリアアクセサリー木工
機能詳細

● 1
● 5
3
体圧分散 (モールドウレタン) ● 1

座面クッションは適度な固さのあるモールドウレタ ンを採用することにより、着座時の安定性が向上 して体圧分散と姿勢保持を両立しています。
食事・多目的ルーム向けチェア
ウェービングテープ構造 ● 2


MCは通常の合板構造とは異なりウェービング テープを使用することでクッション性に優れた座り 心地を実現しています。
コンパクト設計 ● 4
ワイド寸法を510㎜に抑えることで身体か収まり やすくホールド感も向上しています。
リーズナブルな汎用レザー張り ● 3 別張対応 ● 5
※別張、完成品出荷対応可能。お気軽にお問い合わせください。
木製(ナチュラル色)汎用レザー仕様



木製チェア 価格(税抜) サイズ(mm) 梱包才数梱包重量
MC-510NA 26,000円 W510×D560×H775 (SH410)4.7才16kg
仕様/張地:合成皮革 (ポリ塩化ビニ-ル) 座:モ-ルドウレタン+ウェ-ビングテ-プ フレ-ム:成型合板 粉体塗装 入数:2 ●スタッキング可能 (4脚まで)
木製(ブラウン色)汎用レザー仕様








木製チェア 価格(税抜) サイズ(mm)梱包才数梱包重量
MC-510BR 26,000円 W510×D560×H775 (SH410)4.7才16kg 仕様/張地:合成皮革 (ポリ塩化ビニ-ル) 座:モ-ルドウレタン+ウェ-ビングテ-プ フレ-ム: 成型合板 粉体塗装 入数:2 ●スタッキング可能 (4脚まで)
幼保レンタル・リース

座った状態で椅子を引きずらないで下さい。ボルトが緩む恐れがあります。
560mm 410mm ウェービングテープ構造
775 560 1070 680 510 446 (座) 455 41 0 61 0 スタッキング/ 4脚 775 560 1070 680 510 446 (座) 455 41 0 61 0 スタッキング/ 4脚
合板構造(従来品)
775mm 510mm
スタッキング
MC-510NA(PK)
MC-510BR(BJ)
MC-510NA(BJ)
MC-510NA(OR)
MC-510NA
MC-510BR
MC-510NA(OR)
MC-510NA(GN)
●
●
● 3
2 ● 4
PK:ピンク OR:オレンジ GN:グリーン BJ:ベージュ ■カラーサンプル
BJ:ベージュ
■カラーサンプル
345 SOCIA
ダイニングチェア
食事・多目的ルーム向けチェア
DCシリーズ 背の面積を広く設計した事でゆったりとした座り心地を実現
機能詳細

低ホルム仕様 ● 1


スタッキング ● 2

肘付



肘なし






別張対応 ● 3

別張り・完成品出荷承ります。
DC-530とDC-730は指定の張地による別 張対応が可能です。また、通常組立商品とし て出荷しておりますが、希望に合わせて工場 出荷時に組み立てを行う完成品出荷対応が 可能です。お気軽にお問い合わせ下さい。
※別張り、完成品出荷につきましては別途お 見積もり致します。
ゆったり ワイド座面 ● 4




ダイニングチェア (肘付) 価格(税抜) サイズ(mm) 梱包才数梱包重量
DC-530P 27,000円 W535×D580×H770 (SH415)4.9才17kg
仕様/張地:合成皮革 (ポリ塩化ビニ-ル) フレ-ム:成型合板 粉体塗装 入数:2 ●スタッキング可能 (4脚まで)


ダイニングチェア (肘付) 価格(税抜) サイズ(mm) 梱包才数梱包重量
DC-730P 27,000円 W535×D580×H770 (SH415)4.9才17kg
仕様/張地:合成皮革 (ポリ塩化ビニ-ル) フレ-ム:成型合板 粉体塗装 入数:2 ●スタッキング可能 (4脚まで)



ダイニングチェア (肘なし) 価格(税抜) サイズ(mm) 梱包才数梱包重量
DC-430P 27,000円 W535×D580×H770 (SH415)4.9才17kg
仕様/張地:合成皮革 (ポリ塩化ビニ-ル) フレ-ム:成型合板 粉体塗装 入数:2 ●スタッキング可能 (4脚まで)
480 470 (座) 770 41 5 535 580 11 10 760 スタッキング/ 4脚 480 470 (座) 770 41 5 61 0 535 580 111 0 760 スタッキング/ 4脚 480 470 (座) 770 41 5 61 0 535 580 111 0 760 スタッキング/ 4脚 770mm 770mm 770mm
535mm
580mm
415mm 415mm
535mm
535mm 580mm 580mm
415mm
DC-530P(OR)
DC-730P(BJ)
DC-530P
DC-730P
DC-430P
DC-430P(GN)
DC-530P(PK)
DC-730P(BJ)
DC-430P(BJ)
DC-530P(WH)
DC-730P(BK)
PK:ピンク OR:オレンジ GN:グリーン BL:ブルー BJ:ベージュ WH:ホワイト ■カラーサンプル BK:ブラック BJ:ベージュ ■カラーサンプル GN:グリーン BL:ブルー BJ:ベージュ ■カラーサンプル
1
1
2 ● 2 ● 3 ● 3 ● 4 ● 4 ● 4 座った状態で椅子を引きずらないで下さい。ボルトが緩む恐れがあります。 346
DC-430P(BL)
● 1 ●
●
●
木製折り畳みチェア
FC-670P 多機能レザー張り
チェアデスク・収納パーティションテーブルレセプションロビーエクステリアアクセサリー木工
機能詳細

FC-670P(BJ)
● 2
● 3 ● 1
● 4
折り畳み可能 ● 1
折り畳み式なので、持ち運びも楽に行え 収納にも場所を取りません。


使い心地の良い R加工フレーム ● 2
フレームには角を取ったR加工を施して いるので、フレームをつかんだ時の違和 感が少ないやさしい使い心地です。
レザー貼り ● 3
耐アルコールなど多機能
● 4 低ホルム仕様
■カラーサンプル












幼保レンタル・リース

908 400 410 (座) 800 41 5 475 590 122 145 折り畳み/ スタッキング 800mm 475mm 590mm 415mm 折畳みチェア 価格(税抜) サイズ(mm) 梱包才数梱包重量 FC-670P 31,000円 W475×D590×H800 (SH415)2.2才 7kg 仕様/張地:合成皮革 (ポリ塩化ビニ-ル) フレ-ム:成型合板 粉体塗装 入数:1
食事・多目的ルーム向けチェア
折畳み時
PK:ピンク IV:アイボリー OR:オレンジ GN:グリーン LGN:ライトグリーン BJ:ベージュ BL:ブルー
FC-670P(GN)
FC-670P(OR)
FC-670P(IV)
FC-670P
FC-670P(LGN)
FC-670P(PK)
347 SOCIA
FC-670P(BL)
木製折り畳みチェア
FC-570P 豊富なカラーが選べる機能レザー張り
機能詳細

● 2
食事・多目的ルーム向けチェア
折り畳み可能 ● 1 使い心地の良い R加工フレーム ●
折り畳み式なので、持ち運びも楽に行え 収納にも場所を取りません。


● 3 ● 3 ● 1
2 耐アルコールなど多機能 レザー貼り
フレームには角を取ったR加工を施して いるので、フレームをつかんだ時の違 和感が少ないやさしい使い心地です。
■カラーサンプル








































折畳みチェア 価格(税抜) サイズ(mm) 梱包才数梱包重量
FC-570P 29,000円 W475×D590×H800 (SH415)2.2才 7kg
仕様/張地:合成皮革 (ポリ塩化ビニ-ル) フレ-ム:成型合板 粉体塗装 入数:1
908 400 410 (座) 800 41 5 475 590 122 145 折り畳み/ スタッキング
800mm 475mm 590mm 415mm
FC-570P(MD08)
FC-570P(MD40)
FC-570P(MD70)
FC-570P
FC-570P(MD48)
FC-570P(MD79)
FC-570P(MD62)
FC-570P(MD85)
折畳み時
MD89 MD88
MD91 MD90
348
木製チェア
WC-2P 多機能レザー張り
チェアデスク・収納パーティションテーブルレセプションロビーエクステリアアクセサリー木工
機能詳細
WC-2P(OR)
● 2
450mm
食事・多目的ルーム向けチェア

445mm

475mm

● 1
● 1
● 2
やや重みがあり、割れや反りがない。ペンキやステインがよく馴染み、艶出し加工で 美しく仕上がる。加工性も良く、供犠打ちネジ、接着の強度が保たれる。古くから高 級家具や工芸用材として用いられた銘木の一つ。
タモ -Ash- フレーム 耐アルコールなど多機能レザー貼り

■カラーサンプル











木製チェア 価格(税抜) サイズ(mm) 梱包才数梱包重量
WC-2P 44,800円 W445×D475×H765 (SH450)10.4才 15kg 仕様/フレ-ム:天然木 (タモ材) ウレタン塗装 座:成型合板 突板貼り (タモ材) ポリウレタン塗装 張地:合成皮革 (ポリ塩化ビニ-ル) 入数:2

幼保レンタル・リース
WC-2P
475 440(背) 390 765 450 445(座)
765mm
PK:ピンク IV:アイボリー OR:オレンジ GN:グリーン LGN:ライトグリーン BJ:ベージュ BL:ブルー
WC-2P(BJ)
WC-2P(PK)
WC-2P(GN)
WC-2P(BL)
WC-2P(IV)
349 SOCIA
WC-2P(LGN) 使用例1 使用例2
木製チェア
ASO-WC1・WC2T・WC2F
機能詳細 1 3 2 4

2 耐次亜塩素酸
3 タモ -Ash- フレーム やや重みがあり、割れや反りがない。ペンキ やステインがよく馴染み、艶出し加工で美し く仕上がる。加工性も良く、供犠打ちネジ、 接着の強度が保たれる。古くから高級家具 や工芸用材として用いられた銘木の一つ。
ASO-WC2F (aqua clean仕様)

詳細、メンテナンス動画は こちらをご覧ください。


ASO-WC2T (張地なし)

ASO-WC1 1 2 3

談話室・多目的ルーム
1




アクアクリーン加工により、 繊維全てが目に見えない分 子皮膜で覆われています。 皮膜により、汚れが繊維に 浸透するのを防ぎます。 水を加えるだけで汚れが浮き 上がります。 布で拭き取るだけで汚れが落 とせます。
水だけで簡単にお手入れができます。
アクアクリーン®テクノロジーとは、水だけで汚れを落とすことができる生地の加工技術です。目に見えない分子皮膜に より、汚れが繊維に浸透するのを防ぎます。水を加えることで汚れを浮かび上がらせ、簡単に拭き取ることができます。
日常生活のさまざまな汚れに対応できます。
4 別張対応
普段の生活の中でつきやすいコーヒーやワインなどの飲み物、チョコレートやクリームなどの食べ物、また皮脂汚れや泥、 ペットのフンに至るまで、さまざまな汚れを簡単に落とすことができます。
人や環境に配慮した安心・安全な加工。
環境に配慮し、人体に有害な物質が含まれず安全であることを証明するエコテックス®スタンダード100を取得していま す。日本より厳しい諸外国の法規制にも対応できる世界レベルの安全性を保持しています。
スペイン製 Fabric
■カラーサンプル



WH:ホワイト TQ:ターコイズ MS:マスタード GJ:グレージュ
※製法の特性上、繊維の流れる方向により、色が異なって見えることがあります。



タモ -Ash-

ASO-WC2T

背面仕様
ASO-WC2F-NA
木製チェア 価格(税抜) サイズ(mm) 梱包才数梱包重量
ASO-WC2T 38,000円 W445×D475×H765 (SH415)10.4才12kg
仕様/フレ-ム:天然木 (タモ材) ポリウレタン塗装 座:成型合板 突板貼り (タモ材) ポリウレタン塗装 入数:2(1個口)
木製チェア 価格(税抜) サイズ(mm) 梱包才数梱包重量
ASO-WC2F-NA 51,000円 W445×D475×H765 (SH450)10.4才14kg
仕様/フレ-ム:天然木 (タモ材) ウレタン塗装 座:成型合板 突板貼り (タモ材) ポリウレタン塗装 張地:布 (ポリエステル) 入数:2(1個口)
ゆったりワイド座面 2 別張対応 3 1
タモ-Ash- フレーム
やや重みがあり、割れや反りが少ない。ペンキやステインがよく馴染み、艶出し加工で美し く仕上がる。加工性も良く、釘打ちやネジ、接着の強度が保たれる。古くから高級家具材 や工芸用材として用いられた銘木の1つ。

BL:ブルー ■カラーサンプル
475 440(背) 390 765 450 445(座) 475 440(背) 390 765 415 445(座) 560 470 420 765 440 765mm 765mm 765mm 450mm 415mm 440mm 445mm 445mm 470mm 475mm 475mm 560mm 木製チェア 価格(税抜) サイズ(mm) 梱包才数梱包重量 ASO-WC1 41,000円 W470×D560×H765 (SH440)11.9才15.5kg 仕様/張地:布 (ポリエステル) フレ-ム:天然木 (タモ材) ポリウレタン塗装 入数:2(1個口)
ASO-WC2F-NA(WH)
ASO-WC2T(NA)
ASO-WC2F-NA(GJ)
ASO-WC2F-NA(MS)
ASO-WC2F-NA(TQ)
ASO-WC2F-NA(WH)
ASO-WC1(BL)
ASO-WC1
350
ラウンジソファ
LS-600N・600S 多機能レザー張り
機能詳細 2 2 1 1
ライトカラーでありながらクリーンケアが容易です。





LS-600N(背なし)


談話室・多目的ルーム
チェアデスク・収納パーティションテーブルレセプションロビーエクステリアアクセサリー木工 幼保レンタル・リース
タモ -Ash- フレーム 1
やや重みがあり、割れや反りがない。ペンキやステインがよ く馴染み、艶出し加工で美しく仕上がる。加工性も良く、 供犠打ちネジ、接着の強度が保たれる。古くから高級家具 や工芸用材として用いられた銘木の一つ。
耐アルコールなど多機能レザー貼り 2







ラウンジソファ 価格(税抜)サイズ(mm)梱包才数梱包重量
LS-600N 84,000円 W600×D600×H4205.3才 14.8kg
仕様/張地:PVC (ポリ塩化ビニ-ル) 座:木枠 フレ-ム:天然木 (タモ材) ポリウレタン塗装 入数:1(2個口)
LS-600S(背付)





ラウンジソファ 価格(税抜) サイズ(mm) 梱包才数梱包重量
LS-600S 98,000円 W600×D600×H750 (SH420)10.1才 16.9kg
仕様/張地:PVC (ポリ塩化ビニ-ル) 座:木枠 フレ-ム:天然木 (タモ材) ポリウレタン塗装 入数:1(2個口)
□600 435 15 1 750 600 450 600 435 15 1 435mm 755mm 435mm 600mm 600mm 600mm
LS-600N(PK)
LS-600S(GN)
PK:ピンク IV:アイボリー OR:オレンジ GN:グリーン LGN:ライトグリーン BJ:ベージュ BL:ブルー ■カラーサンプル
LS-600N(BJ)
LS-600N(BL)
LS-600N(IV)
LS-600N(GN)
LS-600N(OR) LS-600N
LS-600S(BL)
LS-600S(PK)
LS-600S(BJ)
LS-600S(OR)
LS-600S 351 SOCIA
LS-600S(LGN)
座位サポートベンチ
SPB-600W・1800W
機能詳細
サポート用品 チェア
座位サポート
座の奥行を狭くしています。(SD310㎜) 座の高さを高くしています。(SH500㎜) 2
PVCレザー貼り 2

SPB-600W(1人掛け)


SPB-1800W(3人掛け)

座位サポートベンチ

座の奥行きを浅くすることで楽に 座れ、座高を高くすることで立ち 上がりやすい設計。

■カラーサンプル

座位サポートベンチ 価格(税抜) サイズ(mm) 梱包才数梱包重量
SPB-600W 93,000円 W600×D490×H860 (SH500)6.6才14kg
仕様/張地:合成皮革 (ポリ塩化ビニ-ル) 座:木枠 フレ-ム:スチ-ル 粉体塗装 (ホワイト ) 入数:1

SPB-1800W 199,000円 W1800×D490×H860 (SH500) ▲ 19.5才 ▲
518 350 600 490 500 408 860 310 490 500 1800 1718 350 408 860 310 600 310mm 500mm 860mm 500mm 600mm 490mm 860mm 500mm 1800mm 490mm
価格(税抜) サイズ(mm) 梱包才数梱包重量
37kg 仕様/張地:合成皮革 (ポリ塩化ビニ-ル) 座:木枠 フレ-ム:スチ-ル 粉体塗装 (ホワイト ) 入数:1
1 3 1 3 1 3
SPB-600W(GN)
SPB-600W
SPB-1800W
SPB-600W(PK)
SPB-1800W(PK)
SPB-1800W(GN) GN:グリーン PK:ピンク
352
ラウンジベンチ
L01・L02・L03 多機能レザー張り
チェアデスク・収納パーティションテーブルレセプションロビーエクステリアアクセサリー木工
機能詳細 1
ライトカラーでありながらクリーンケアが容易です。

L01(1人掛け)


L02(2人掛け)
談話室・多目的ルーム
ちょっと座りたいに最適なコンパクトな ベンチです。一人掛けから三人掛けと テーブル付をラインナップしました。 床の掃除も楽々です。
耐アルコールなど多機能レザー貼り 1

■カラーサンプル




ラウンジベンチ 価格(税抜)サイズ(mm)梱包才数梱包重量
L01B 58,000円 W500×D500×H4301.8才8.5kg
L01W 58,000円 W500×D500×H4301.8才8.5kg
仕様/座:合板 スラブウレタン+チップウレタン PVC張り 脚:スチ-ル (〼31mm) 粉体塗装 入数:1(1個口)
L02T(1人掛けテーブル付)


ラウンジベンチ 価格(税抜)サイズ(mm)梱包才数梱包重量
L02B 92,700円 W1000×D500×H4303.5才14kg
L02W 92,700円 W1000×D500×H4303.5才14kg
仕様/座:合板 スラブウレタン+チップウレタン PVC張り 脚:スチ-ル (〼31mm) 粉体塗装 入数:1
L03(3人掛け)


※テーブルのみ ■カラーサンプル

ラウンジベンチ(天板付) 価格(税抜)サイズ(mm)梱包才数梱包重量
L02TB 91,600円 W1000×D500×H4303.5才15kg
L02TW 91,600円 W1000×D500×H4303.5才15kg
仕様/座:合板 スラブウレタン+チップウレタン PVC張り 天板:抗ウイルスメラミン 抗ウイルスABSエッジ 天板裏:抗ウイルスバッカ- 脚:スチ-ル (〼31mm) 粉体塗装 入数:1(1個口)

ラウンジベンチ 価格(税抜)サイズ(mm)梱包才数梱包重量
L03B 112,000円 W1500×D500×H4305.3才18kg
幼保レンタル・リース
L03W 112,000円 W1500×D500×H4305.3才18kg
仕様/座:合板 スラブウレタン+チップウレタン PVC張り 脚:スチ-ル (〼31mm) 粉体塗装 入数:1 (1個口)
430 418 500 290 398 500 430 918 500 290 500 1000 398 500 352 918 398 500 500 290 500 1000 430 430 1418 398 500 500 290 500 1500 500 430mm 500mm 500mm 430mm 430mm 1000mm 1500mm 500mm 500mm
ブルー
L03W(BL)
LO1B(LGN)
LO1W(PK)
LO1W(BL)
LO2B(IV)
LO2W(LGN)
LO2TW(PK) LO3B(BL) LO3W(IV)
LO1B・LO1W LO2B・LO2W LO2TB・LO2TW LO3B・LO3W
LGN:ライトグリーン
BL:ブルー PK:ピンク IV:アイボリー
NA:ナチュラル
353 SOCIA
WE-SC1
浴室で

木目調を配した落ち着いた色合いのシャワーチェア。
浴室や脱衣所はもちろん、自室でも使用可能。
撮影協力 なごや福祉用具プラザ
玄関で


シャワーチェア
自室で
WE-SC1 WE-SC1 354

シャワーチェア
WE-SC1
チェアデスク・収納パーティションテーブルレセプションロビーエクステリアアクセサリー木工

洗いやすいワイドな設計、利用者に合わせる高さ調節、背の付け外しや肘向き調整など、 機能満載で利便性に富んだシャワーチェア。
機能詳細

1 高さ調節(工具不要)



■5段階で高さの調節が可能。 (20㎜ピッチ)
固定ピン スライド脚

固定ピン式なので 工具を使わず、簡単に 高さが調節できます。
2 肘の高さ


4 ゴムキャップ
滑りにくいゴム製 脚キャップ

3 ワイド設計

■背の向きを前後付け替えることで 立ち上がり易さを選択できます。
5 背の取外し・付替え

■プッシュピンを押すことで、背パイ プの固定が解除されます。 背を抜き取れば背なし状態逆側か ら差し込み固定することで肘向き を変える事が可能です。

■着座状態での洗い易さを 考慮したワイドな設計に なっています。



幼保レンタル・リース
BR:ブラウン
750~850mm 400~500mm 400~500mm 600~700mm 600~700mm 550~565mm 625mm 625mm 550~565mm (座)470mm (肘)625mm プッシュピン 背パイプ 670 690 550 565 670 690 515 545 625 (肘) 470 (座) 400 (背) 670 690 550 565 670 690 515 545 シャワーチェア 価格(税抜) サイズ(mm) 梱包才数梱包重量 WE-SC1 31,000円 W625×D550~565×H750~850 SH400~500mm2.1才3.6kg 仕様/背・座:樹脂成型品 フレーム:アルミ 粉体塗装 入数:1 ●高さ調節機能付き ●背着脱可能
サポート用品 チェア
1 1 5 4 4 2 2 3 3
WE-SC1 355 SOCIA
■背カラーサンプル
WG-51・WG-53

機能詳細
座面部分は水をはじいて 滑りにくいEVA樹脂を採用。

高さ調節(工具不要) 1


■高さ調節が5段階で可能です。 (25mmピッチ)




脚の高さはボタン式。組立ネジにも樹脂ツマミ式を 採用し、工具を一切使用しません。

水をはじくEVA樹脂製の マット すべりにくいゴム脚 キャップ
WG-51


立ち上がりやすい取手 シャワーヘッド用フック

写真はWG-51、WG-53
シャワーチェア 価格(税抜) サイズ(mm) 梱包才数梱包重量
WG-51 12,800円 W510~520×D425~450×H415~515 (SH385~485)5.1才11kg 仕様/座:樹脂成型品 (ポリエチレン) マット:樹脂成型品 (EVA) フレ-ム:アルミ アルマイト仕上げ 入数:4 ●高さ調節機能付 (5段階/25mmピッチ)
WG-53

シャワーチェア 価格(税抜) サイズ(mm) 梱包才数梱包重量
WG-53 17,100円 W510~520×D455~475×H775~875 (SH385~485)6.8才15kg
仕様/座:樹脂成型品 (ポリエチレン) マット:樹脂成型品 (EVA) フレ-ム:アルミ アルマイト仕上げ 入数:4 ●高さ調節機能付 (5段階/25mmピッチ)
310(座)
490~520425~450
310(座)
490~520425~450
385 ~ 485mm 385 ~ 485mm 775 ~ 875mm
510~520mm
425~450mm 455~475mm 510~520mm
510(座)
415 ~ 515 385 ~ 485
390(背) 510(座)
455~475
775 ~ 875 385 ~ 485
シャワーチェア
サポート用品 チェア WG-51 WG-53
4 5 5 2 1 3 2 4 1 3
EVAマット 2 ゴムキャップ 3 便利な取っ手 4 シャワーヘッド フック 5
WG-53 356
WG-51
背上式ベッド
機能詳細 1 2

背上式 1
・簡単レバー操作のガスシリンダー式角度調節機能付 ・背部0° 65°

ガスシリンダー式角度調節 無段階0 65°
・通気性の高い75㎜間隔メッシュ構造。 ・床面を保護する足ゴム付き。
背上式MCベッド 価格(税抜) サイズ(mm) 梱包才数梱包重量
KTB-1498 199,000円 W980×D2070×H350~670 ▲ 18.7才 ▲ 50kg 仕様/本体:スチ-ル 粉体塗装 入数:1 ●ガスシリンダ-式角度調節機能付 (無段階0~65°)
マットレス








HAマットレス 価格(税抜)サイズ(mm)梱包才数梱包重量 KTB-1161 81,000円 W910×D1910×H60 ▲ 5.3才 5kg 仕様/張地:綿 クッション材:ウレタンフォ-ム 入数:1
GN:グリーン CM:キャメル BR:ブラウン BL:ブルー YE:イエロー WH:ホワイト PK:ピンク ■カラーサンプル 357 SOCIA
幼保レンタル・リース
チェアデスク・収納パーティションテーブルレセプションロビーエクステリアアクセサリー木工
アルミ製自走式車イス
WE-K1
施設などの使用に最適なノーパンクタイヤ仕様の スタンダードモデル

フットサポート 1


フットサポートは跳ね上げることができ、乗降時に邪魔にならないように したり、折りたたみの際にコンパクトにすることができます。

介助者が操作するブレーキ。


TAIS

フットサポートが取り外せるため、足こぎが可能です。
レッグサポート 2

脚を後ろに落とさないサポート付

背面ポケット付き。 折りたたみしやすいクロス パイプ構造。 介助ブレーキにはドラム 式を採用。
サイドガード 3

タイヤに衣類を巻き込まない安全装備。
9

段差などで介助者が、前輪を 上げる時に足をかけて踏み込 むためのレバー。

車イスを停止又は、制 動するためのブレーキ。
■カラーサンプル
BK:ブラック

アルミ製自走式車イス WE-K1 400 600 1000 865 450435 415 265 670 1000 310 アルミ製自走式車イス WE-K1 400 600 1000 865 450435 415 265 670 1000 310 アルミ製自走式車イス WE-K1 400 600 1000 865 450435 415 265 670 1000 310 アルミ製自走式車イス WE-K1 400 600 1000 865 450435 415 265 670 1000 310 アルミ製自走式車イス WE-K1 400 600 1000 865 450435 415 265 670 1000 310 アルミ製自走式 車イス 価格(税抜) サイズ(mm) 梱包才数梱包重量 WE-K1 66,000円 W600×D1000×H865 (SH435)7.1才15.8kg 仕様/張地:ポリエステル フレ-ム:アルミ クッション材:ウレタンフォ-ム 入数:1 ●フットサポ-ト3段階調節機能付 ●耐荷重100kg ●製品荷重12.3kg
福 祉 用 具
WE-K1 1 3 2 4 5 6 7 8 9 9
ティッピングレバー
背面ポケット 7 クロスパイプ
ドラムブレーキ
介助ブレーキ
コード:02007-000001 機能詳細
8
6
5
4
タックル ブレーキ
358
昇降式手すり
WE-CT5050
チェアデスク・収納パーティションテーブルレセプションロビーエクステリアアクセサリー木工
機能詳細

ご利用者の体形に合わせて使いやすい高さに設定できます。 用途に合わせて高さ調整ができ、いろいろな場面で使えます。 出来ることを増やし自立した生活へ。


福 祉 用 具
昇降式手すり 価格(税抜) サイズ(mm)梱包才数梱包重量 WE-CT5050+WE-CT5050-MAT-A/MAT-B/MAT-C 119,600円 W500×D500×H800~10003.4才1.4kg 仕様/グリップ:天然木 粉体塗装 支柱:スチ-ル 粉体塗装 縁ゴム マット:ポリ塩化ビニ-ル 入数:1 ●手すり昇降 (ガスシリンダ-式) 機能付 ●組立時に支柱の取り付け位置 (中央・端) 、シリンダ- (内側・外側) が選べます。 最大1000mm 最小800mm
WE-CT5050(本体)
製品重量 : 16kg
手すり 端取り付け例


ガスシリンダー式 昇降機能 高さ調整 1
手すりの高さは、800~ 1000㎜の任意の位置で 無段階調節可能。
手すり 中央取り付け例

昇降式手すり 価格(税抜) サイズ(mm) 梱包才数梱包重量 WE-CT5050 115,000円 W500×D500×H800~10003.4才 14kg 仕様/グリップ:天然木 粉体塗装 支柱:スチ-ル 粉体塗装 縁ゴム 入数:1 ●手すり昇降 (ガスシリンダ-式) 機能付 ●組立時に支柱の取り付け位置 (中央・端) 、シリンダ- (内側・外側) が選べます。
マット (オプション)
5

WE-CT5050-MAT-A
Aタイプ 端取り付け シリンダー 外側用

Bタイプ 端取り付け シリンダー 内側用

Cタイプ 中央取り付け用
昇降式手すり用マット 価格(税抜)サイズ(mm)梱包才数梱包重量
仕様/マット:ポリ塩化ビニ-ル 入数:1
玄関での使用例 トイレ使用例





シリンダーカバーに カラーテープを貼る ことで、普段お使いの 高さへ再調整が容易に なります。 H1000㎜の高さで生活 を快適に。
支柱取付位置 2

組立時に支柱の取付位置(中央・端)、 シリンダー位置(内側・外側)が選べます。


木製グリップ 3 ワンタッチ調整 4
寒い日でも安心の木製 グリップ 手すりの高さをレバー 1本で簡単に調整する ことが可能。
マット(オプション) 5
温かみのある木目調の マットを採用。
マットを敷くことで、 失禁時の拭き上げや掃除 も容易に!
手すりを取付ける位置に より、お選びください。

幼保レンタル・リース

WE-CT5050-MAT-A 4,600円 〼475×t20.01才 0.5kg WE-CT5050-MAT-B 4,600円 〼475×t20.01才 0.5kg WE-CT5050-MAT-C 4,600円 〼475×t20.01才 0.5kg
TAIS コード:02007-000002
WE-CT5050 (本体) + WE-CT5050-MAT-A (マット)
WE-CT5050 + WE-CT5050-MAT-B
1 2 3
WE-CT5050 + WE-CT5050-MAT-C
4 5
WE-CT5050-MAT-B
WE-CT5050-MAT-C
359 SOCIA
ハンドレールステッキⅡ
手すり感覚で使用できる車輪付きステッキです。
グリップ(広幅仕様)
ハンドルは軽く操作 できるので方向変え がスムーズです。
サイズ調整用ネジ
ブレーキ (サイドブレーキ付) 伸長に合わせて 高さ調整が可能 です。
面ファスナーと受けで 傘やステッキの固定も できます。
折畳用フック 反射テープ 受け
1
軽量なので持ち運びに便利 折畳は付属のフックで簡単に固定でき ます。但し、荷物を掛けた状態では折 畳むことはできません。

前輪は安定感のある大型車輪で 段差や溝もスムーズに超えます。
後輪は歩く際に足に当たり にくく幅をせまくしています。 2
2 荷物掛け用フック

対応身長 : 約150~175㎝
前輪は固定とフリーがワンタッチで 切替可能(特許取得済)
【 固定 】


【 フリー 】 3
ハンドルが固定されるので一般的なサイド カートとして使用できます。
ハンドルを斜めにして荷重を掛けながら使 用できます。( ステッキ斜め突き同様 )
買い物袋やかばんを掛ける フックが付いているので便利
・荷物掛けることにより重心が安定します。
・傘やステッキを持ち運ぶこともできます。

ステッキと一緒に使うとより 安定して歩行することが可能

固定 フリー

ワンタッチ切替(特許取得済)

ハンドレールステッキ Ⅱブーケ 価格(税抜) サイズ(mm)梱包才数梱包重量
WB5135 オープン W170×D450×H760~8801.6才2.5kg
仕様/グリップ:ポリプロピレン、エラストマ- フレ-ム:アルミニウム 車輪:ポリプロピレン樹脂成型品、EVA ブレ-キレバ-:アルミダイカスト 入数:1 ●対象身長:150~175 ㎝ ●前輪切り替え機能付 ●駐車ブ レ-キ付 ●ハンドブレ-キ付 ●5段階高さ調節機能付
正しい使い方でご使用ください。
ハンドレールステッキ Ⅱブラック 価格(税抜) サイズ(mm)梱包才数梱包重量 WB5134 オープン W170×D450×H760~8801.6才2.5kg 仕様/グリップ:ポリプロピレン、エラストマ- フレ-ム:アルミニウム 車輪:ポリプロピレン樹脂成型品、EVA ブレ-キレバ-:アルミダイカスト 入数:1 ●対象身長:150~175 ㎝ ●前輪切り替え機能付 ●駐車ブ レ-キ付 ●ハンドブレ-キ付 ●5段階高さ調節機能付
腰の横に近づけて体で押すような感じで使います。 ・グリップ部を体の前に出したり、腰から離して使用すると、ハンドルがフラフラして安定しないので危険です。
WB5135
WB5134
1
360
3 WB5135 ブーケ
Twin Z StickⅡ
斬新なデザインと歩行・立ち座りに効果を発揮
チェアデスク・収納パーティションテーブルレセプションロビーエクステリアアクセサリー木工
2

TWin Z Stick Ⅱ 価格(税抜)
福 祉 用 具
: 約155~165㎝
Made in Japan
1 2 強くて軽いマグネシウム合金 歩行・立ち座り時に便利
高強度マグネシウム合金を採用、 軽さと高強度を両立。
歩行時だけではなく、立ち座り時にも 腰・膝への負担が軽減。


温もりのあるコルクグリップ 歩行時
立ち上がり時
右手は順手、左手は逆手での使用に なります。 シャンパンコルク栓のリユースで す。コルク栓のリサイクルは障 がい者の仕事づくりに役立って います。
サイズ(mm) 梱包才数梱包重量
WB5240/WB5238/WB5239 オープン W200×D290×H8101.7才 1.3kg 仕様/グリップ:コルク シャフト:高強度マグネシウム合金 杖先:ポリプロピレン、天然ゴム 入数:1 ●対象身長:155~165 ㎝
かるがも®4ポイントステッキ
濡れた路面や傾斜面でも滑りにくい外出用多点杖

かるがも®4ポイントステッキ 価格(税抜)

マグネシウムシャフトで驚きの軽さ フラミンゴN

対応身長 : 約138~182㎝
シャフト径 : 上22㎜ 下19㎜ 1 1 2 2
Made in Japan
従来品と比較して約100g軽くしました。(ジュラルミン採用) 高級感のある柄「バーズアイシリーズ」
4つの支点が威力を 発揮 !
フラミンゴN伸縮ステッキ 価格(税抜)
WB3882/WB3885/WB3886 WB3883/WB3884/WB5212


伸縮ステッキ

DX先ゴム

4つの支点が角度に合わせて約 10度まで動き、スロープや階段な ど滑りやすい所の路面をしっかりと 捕らえます。また自立して置くことも 可能です。
サイズ(mm) 梱包才数梱包重量
WB3826/WB3827/WB3828 オープン W106×D106×H710~9300.4才 0.9kg 仕様/グリップ:ポリウレタン、エラストマ- シャフト:アルミニウム ベ-ス部:ジュラルミン 可動部:アルミニウム 先ゴム:合成ゴム 入数:1 ●対象身長:138~182 ㎝ ●10段階高さ調節機能付 (25mmピッチ) ●TAISコード:00121-000015(WB3826) TAISコード:00121-000016(WB3827/WB3828)
サイズ(mm) 梱包才数梱包重量




斜めから地面を突いてもしっかり と地面を捉え続ける4点DX先ゴ ムを採用しています。
対応身長 : 約146~176㎝
シャフト径 : 上22㎜ 下19㎜ 先ゴム : 19㎜ DX

交換可能なソフトグリップ 1
Made in Japan 手に優しく安心の太さで軽量です。

DX先ゴム 2 DX先ゴム 3

幼保レンタル・リース
斜めから突いても安 定感のあるDX先ゴ ムを採用
先ゴムの角度が接地 面に合わせて変わるの で、地面を突いた時に 安定感があります。
オープン H770~910 0.4才 0.4kg 仕様/グリップ:ポリウレタン シャフト:高強度マグネシウム合金 ストラップ:ナイロン 先ゴム:合成ゴム 入数:1
対応身長
1
WB5240 フォレストグリーン
WB3826 ステンカラー
WB3882 ラベンダー WB3885 コーラルピンク WB3886 バーガンディ WB3883 フォレストグリーン WB3884 ディーブレッド WB5212 サテンブラック
WB3827 バーズアイレッド
WB3828 バーズアイシルバー
WB5238 オフホワイト
WB5239 ディーブレッド
1 2 3
361 SOCIA
Kindergarten

清潔なものを贈る
Rental / Lease

「子どもの触れる場所、すべてに気を遣いたい」 家具を通して『あんしん』を届ける、 そんな思いを形にしました。
抗菌素材で編んだバスケット SIAA ISO22196 抗菌規格取得
抗菌とは
製品の表面上における細菌の繁殖を抑制すること、 長期に亘って菌を増やさない様にすることを言います。 ※細菌を一時的に死滅・除去する殺菌・除菌とは区別されます。
SIAAとは
SIAA(抗菌製品技術協議会)は適正で安心できる 抗菌・防カビ・抗ウィルス加工製品の試験機関です。 抗菌・防カビ・抗ウィルス加工製品に関する品質や 安全性のルールを整備し、適合した製品に 安心のシンボルSIAAマークを認証しています。
■ お子様も安心して使える抗菌ピクニックバスケット ※画像のバスケットは持ち手をカスタマイズしております。

362
手編みカゴ
抗菌手編みバスケット Sシリーズ 安心を編む。100%抗菌PP+PE素材













ストレージかご 価格(税抜)サイズ(mm)梱包才数梱包重量
S-SK 13,000円 W410×D310×H2301.2才 1.4kg
仕様/本体:ポリプロピレン樹脂成型品+ポリエチレン樹脂成型品 入数:1 ●丸洗い可能




スクェアバスケット 価格(税抜)サイズ(mm)梱包才数梱包重量
S-SB 13,800円 W370×D280×H3601.7才 1.5kg
仕様/本体:ポリプロピレン樹脂成型品+ポリエチレン樹脂成型品 入数:1 ●丸洗い可能




オーバルバスケット
価格(税抜)サイズ(mm)梱包才数梱包重量 S-OB 17,500円 W470×D340×H3502.3才 1.6kg
仕様/本体:ポリプロピレン樹脂成型品+ポリエチレン樹脂成型品 入数:1 ●丸洗い可能



幼保レンタル・リース

ダストボックス
価格(税抜)サイズ(mm)梱包才数梱包重量 S-DB 9,000円 φ285×H320 1.2才 1.2kg
仕様/本体:ポリプロピレン樹脂成型品+ポリエチレン樹脂成型品 入数:1 ●丸洗い可能
S-SK(LGR)
S-SK(DGR) S-SK(LBJ)
S-SK(BR)
S-SB(LBJ) S-SB(WH)
S-SB(DGR)
S-SB(BR)
S-OB(WH)
S-OB(LGR)
S-OB(DGR)
S-OB(BR)
S-DB(WH)
S-DB(LBJ)
S-DB(BR)
S-DB(LGR)
WH:ホワイト LGR:ライトグレー LBJ:ライトベージュ DGR:ダークグレー BR:ブラウン ■カラーサンプル
363 SOCIA チェアデスク・収納パーティションテーブルレセプションロビーエクステリアアクセサリー木工
絵本ラック

KUMI-350H(NA)+KUMI-350F(GN)
ENR-O ENR-S

絵本ラックオープン

価格(税抜)サイズ(mm)梱包才数梱包重量
ENR-O 94,000円 W890×D300×H9002.1才17.4kg
仕様/本体:抗ウイルスプリント紙化粧板貼り 入数:1 ●可動棚3枚付 (10mmピッチ)
共通項目

ブックエンド 可動棚にはブックエンドを 取り付けることが可能。

可動棚 10mmピッチで棚板を動かす ことが可能。


絵本ラックスタンド 価格(税抜)サイズ(mm)梱包才数梱包重量
ENR-S 98,000円 W890×D300×H9002.1才20kg
仕様/本体:抗ウイルスプリント紙化粧板貼り 入数:1 ●可動棚3枚付 (10mmピッチ)
890 95 900 274 300 21 0 560 855 273 216 217 9 94 98 890 95 900 274 300 21 0 560 855 273 150 1 10 216 9276 9 94 98
ENR-O ENR-S ENR-O ENR-S 使用例 使用例
ENR-O ENR-S 364
絵本ラック
抗ウイルスプリント紙を採用した感染症対策の絵本ラックシリーズです。 小さな子供がいる場所でも安心して使用できます。
チェアデスク・収納パーティションテーブルレセプションロビーエクステリアアクセサリー木工


ENR-K

ENR-K+KUMI-350H(IV)×2+KUMI-350F(GN)×2
絵本ラックkumiki 価格(税抜)サイズ(mm)梱包才数梱包重量 ENR-K 82,000円 W800×D400×H8202.0才19kg 仕様/本体:抗ウイルスプリント紙化粧板貼り 入数:1
箱 クッション



KUMI-350H 47,500円 W350×D350×H4254.2才6.9kg 仕様/本体:パ-ティクルボ-ド ポリ化粧板 小口テ-プ貼り アジャスタ-:ポリエチレン 入数:1 使用例
箱 価格(税抜)サイズ(mm)梱包才数梱包重量





クッションPVC張り 価格(税抜)サイズ(mm)梱包才数梱包重量 KUMI-350F 15,100円 W350×D350×H400.3才1.7kg 仕様/クッション:合板 スラブウレタン+チップウレタン 合成皮革 (PVC) 入数:1


800 240 820 104 400 297 501 759 126 378 180 120 83
ENR-K
KUMI-350H(IV) KUMI-350H(NA)
KUMI-350F(BJ)
本体収納 ENR-K
KUMI-350F(GN) コーナーキャップ
NA:ナチュラル IV:アイボリー ■カラーサンプル GN:グリーン BJ:ベージュ ■カラーサンプル 365 SOCIA
幼保レンタル・リース
キッズガーデン

付属のすべり止めシート(4枚)で 連結します。

国産のノンフタル酸レザーを使用。
他にも抗菌・耐次亜塩酸・耐アルコール機能も付いています。


スツール (大) (小) 価格(税抜)サイズ(mm)梱包才数梱包重量
KSC-1150
64,000円 W1150×D250×H2502.9才9kg
KSC-900 55,000円 W900×D250×H2502.3才7.5kg
仕様/張地:合成皮革 (PVC) クッション材:ウレタンフォ-ム 入数:1


シューズBOX 価格(税抜)サイズ(mm)梱包才数梱包重量
KSC-B925 104,000円 W900×D250×H2502.3才6.3kg
仕様/張地:合成皮革 (PVC) クッション材:ウレタンフォ-ム 本体:ポリ化粧板 (シュ-ズBOXのみ) 入数:1



クッション 価格(税抜)サイズ(mm)梱包才数梱包重量
KSC-K10 16,800円 φ200×H2020.4才1kg
KSC-K20 18,900円 △200×H2000.4才1kg
KSC-K30 16,800円 〼200×H2000.4才1kg
仕様/張地:合成皮革 (PVC) クッション材:ウレタンフォ-ム 入数:1
■張地カラーサンプル スツール シューズBOX クッション

BJ:ベージュ
マット 入口マット コーナーマット

BJ:ベージュ


OR:オレンジ YE:イエロー

IV:アイボリー

IV:アイボリー



マット (入口・コーナー) 価格(税抜)サイズ(mm)梱包才数梱包重量
KSC-C1150 79,000円 W1150×D1150×H402.5才8.5kg
KSC-I250 35,000円 W900×D250×H400.4才2.3kg
KSC-M90 49,000円 W900×D900×H401.5才5.6kg
仕様/張地:合成皮革 (PVC) クッション材:ウレタンフォ-ム 入数:1
KSC-1150(IV)
KSC-900(YE)
KSC-B925(OR)
KSC-B925(YE)
KSC-K10(BJ) KSC-K20(YE)
KSC-K30(OR)
KSC-M90(BJ)
KSC-C1150(IV)
KSC-I250(BJ)
KSC-1150(OR)
KSC-B925(YE)
KSC-C1150(IV)
KSC-900(OR)
366
KSC-K30(OR)
アニマルガーデン
チェアデスク・収納パーティションテーブルレセプションロビーエクステリアアクセサリー木工

付属のすべり止めシート(4枚)で 連結します。

アニマル柄がプリントされた多機能PVCを使用し 芯材には全てクッションを使用した安全設計になっています。



スツール (サイド・コーナー) 価格(税抜)サイズ(mm)梱包才数梱包重量
AG-RS1200 56,000円 W1200×D250×H2002.9才8.6kg
仕様/張地:合成皮革 クッション材:チップウレタン 入数:1
スツール (サイド・コーナー) 価格(税抜)サイズ(mm)梱包才数梱包重量
AG-SS950 41,500円 W950×D250×H2002.3才8.4kg
仕様/張地:合成皮革 クッション材:チップウレタン 入数:1
■スツール・クッションカラーサンプル






クッション 価格(税抜)サイズ(mm)梱包才数梱包重量
AG-KMA 19,800円 φ200×H2000.4才1kg
AG-KSA 19,800円 W200×D170×H2000.3才1kg
AG-KSI 19,800円 W200×D200×H2000.4才1kg
仕様/張地:合成皮革 クッション材:チップウレタン 入数:1
乳幼児向けのハイハイスロープマットは適度な運動も行えます。



■マットカラーサンプル

IV:アイボリー
幼保レンタル・リース
マット 価格(税抜)サイズ(mm)梱包才数梱包重量
AG-MAS 66,000円 W950×D950×H2007.4才5.3kg
AG-SAS 66,000円 W950×D950×H2007.4才4.8kg
AG-SMA 34,500円 W950×D950×H452.5才6.4kg
仕様/張地:合成皮革 クッション材:チップウレタン 入数:1
AG-SS950(BL)
AG-RS1200(PK)
AG-RS1200(YE)
AG-KMA(PK)
AG-KSA(YE)
AG-KSI(BL)
AG-SMA(IV)
AG-SAS(IV)
AG-MAS(IV)
YE:イエロー PK:ピンク BL:ブルー
AG-SS950(BL)
AG-SS950(PK)
367 SOCIA
AG-RS2300(BL)

AG-WM

両面テープが付いているマジックテープを、マットの裏側のマジックテープの高さと同じ になる位置に貼り付けてください。
■カラーサンプル

IV:アイボリー
■カラーサンプル



KE-WM


高さ100cmまでクッションで保護することが可能です。 上下の両面テープで簡単に施工できます。



AG-WM(IV) AG-WM(BL) AG-WM(PK) AG-WM(YE)

ウォールマット 価格(税抜)サイズ(mm)梱包才数梱包重量
AG-WM 24,500円 W500×D30×H10001.0才 4kg
仕様/張地:合成皮革 クッション材:ウレタンフォ-ム 入数:1

パンチングメッシュ仕様

両面テープが付いているマジックテープを、マットの裏側のマジックテープの高さと同じ になる位置に貼り付けてください。
■カラーサンプル

IV:アイボリー
ウォールマット 価格(税抜)
サイズ(mm) 梱包才数梱包重量
KE-WM 32,000円 W500×D30×H1000mm1.0才 3.6kg
仕様/張地:合成皮革 クッション材:ウレタンフォーム 入数:1
ウォールマット
YE:イエロー PK:ピンク BL:ブルー
KE-WM(IV) 368
園児用ベンチ
チェアデスク・収納パーティションテーブルレセプションロビーエクステリアアクセサリー木工


(ブル-) 脚:アルミアルマイト 入数:4 ●スタッキング可能 (4台まで)
キッズソファベッド
普段はソファとして、
軽量なアルミフレームを採用しています。 屋外の使用でも熱くなりにくい樹脂製 の座です。
脚部ゴムキャップ裏側はフラットで小 石などが入らないようになっています。




スタッキング座板間 スタッキング緩衝ゴム 脚部ゴムキャップ
■カラーサンプル

緊急時にはベッドとして使用できます。 GN:グリーン IV:アイボリー




幼保レンタル・リース
375 327 330 300 1205 375 460 1267 299 196 948 スタッキング/ 3脚 1270 295 1270 510 1400 600 620 170 345 340 園児用ベンチ 価格(税抜)サイズ(mm)梱包才数梱包重量 ENB-1200 54,000円 W1205×D375×H3306.4才17.3kg 仕様/座:樹脂成型品
キッズソファベッド 価格(税抜) サイズ(mm) 梱包才数梱包重量 K-SOB 152,000円 W1400×D600×H510 (SH295)11.7才 24kg 仕様/張地:合成皮革 (ポリ塩化ビニ-ル) 本体:木 入数:1 ●リクライニング4段階 ●ベッド時寸法:W1400×D620×H340
ベッド時
K-SOB
リクライニングイメージ
ENB-1200(BL)
スタッキング例
ENB-1200
369 SOCIA
K-SOB
抗ウイルス長方形テーブル
キャスター付で移動・収納が簡単に行えます。
スタックテーブル角 価格(税抜)サイズ(mm)梱包才数梱包重量
ENT-K330V 76,000円 W1300×D600×H51016.0才23kg 仕様/天板:抗ウイルスメラミン化粧板 (t28mm) 抗ウイルスソフトエッジ 天板裏:抗ウイルスバッカ- 脚:スチ -ル メラミン焼付塗装 (ホワイト) キャスタ-:ストッパ-付2個 入数:1 ●スタッキング可能 (3台まで)


エッジ色
天板色 IV:アイボリー NA:ナチュラル


WH:ホワイト PK:ピンク GN:グリーン NA:ナチュラル


■ENTテーブル共通仕様 天板表面、エッジ、天板裏は全て 抗ウイルスなので安心です。

ENT-K330V(NA)

スタッキング例
抗ウイルス台形テーブル
スタックテーブル台 形 価格(税抜)サイズ(mm)梱包才数梱包重量
ENT-D330V 77,000円 W1270×D520×H51013.0才17kg
仕様/天板:抗ウイルスメラミン化粧板 (t28mm) 抗ウイルスソフトエッジ 天板裏:抗ウイルスバッカ- 脚:スチ -ル メラミン焼付塗装 (ホワイト) キャスタ-:ストッパ-付2個 入数:1 ●スタッキング可能 (3台まで)

ENT-K330V(GN)

ENT-K330V(WH)

ENT-K330V(PK)

ENT-D330V(PK)

ENT-D330V(GN)
抗ウイルス5段階テーブル
園児の成長に合わせて長く使える昇降式テーブル。
折りたたみ式で場所を取らずに収納できます。
5段階テーブル 価格(税抜) サイズ(mm)梱包才数梱包重量
ENT-1260V 71,000円 W1200×D600×H365~4852.4才21kg
ENT-9060V 68,000円 W900×D600×H365~4851.8才17kg 仕様/天板:抗ウイルスメラミン化粧板 (t28mm) 抗ウイルスソフトエッジ 天板裏:抗ウイルスバッカ- 脚:スチ -ル メラミン焼付塗装 (ホワイト) アジャスタ- 入数:1 ●5段階 (30mmピッチ) で高さ調節が可能です。

ENT-1260V(NA)

ENT-9060V(WH)


ENTセット例
65 1200/900 915/665 975/725 600 441 508 365 ~ 485 223 ~ 343 365~485 510 421 590 688 1200 1206 1270 520 393 スタッキング/ 3台 353 450 520 2170 2500 1200 421 1200 1236 1300 600 521 スタッキング/ 3台 1016 450 510 680 688
ENT-K ENT-D ENT 370
FC(高さ調整脚タイプ)
チェアデスク・収納パーティションテーブルレセプションロビーエクステリアアクセサリー木工

FC-1260(YE)
折畳みテーブル 価格(税抜) サイズ(mm)梱包才数梱包重量
FC-1260 89,000円 W1200×D600×H360~5602.8才14kg 仕様/天板:メラミン化粧板 (t28mm) ソフトエッジ 脚:バネ脚 スチ-ル (〼26mm) メラミン焼付塗装 (シルバ-) 入数:1 ●折畳時:H91mm ●高さが5段階で変更できます。


FCK(平板脚タイプ)

FCK-1260(BL)
折畳みテーブル 価格(税抜)サイズ(mm)梱包才数梱包重量
FCK-1260 69,000円 W1200×D600×H3302.8才13.5kg 仕様/天板:メラミン化粧板 (t28mm) ソフトエッジ 脚:クランク脚 スチ-ル (〼26mm) メラミン焼付塗装 (アイ ボリ-) 入数:1 ●折畳時:H91mm
園児用イス
FC-1260(BL)



調節つまみ部 つまみ部を引き出し、脚フレームを 上下させ高さを変えることができます。

5段階高さ調節 H360~H560の5段階で 高さ調節ができます。

FCK-1260(PK)

アイボリー塗装の クランク平板脚を採用。
身長110cmぐらいの園児に最適なサイズです。



幼保レンタル・リース
(3脚まで)

320 290 475 385 610 275 (座) 340 スタッキング/ 4脚 520 600 1200 1079 36 0・ 410 46 0・ 51 0・ 560 530 91 30 5・ 355 40 5・ 45 5・ 505 折り畳み時 600 1200 1085 330 275 530 91 折り畳み時 学習イス 価格(税抜) サイズ(mm) 梱包才数梱包重量 ENC-250 39,000円 W320×D385×H520 (SH290)4.3才6kg 仕様/背・座:天然木 脚:パイプ
入数:5 ●スタッキング可能
(φ19.1mm) 粉体塗装 (ベ-ジュ)
使用例 スタッキング例
ENC-250
PK:ピンク YE:イエロー BL:ブルー ■天板色 FC-1260
ENC-250 371 SOCIA
FCK-1260
Rental / Lease
樹脂テーブル天板(W1800×D450タイプ)
天板を交換するなら、水に強い樹脂天板 使用している脚フレームを再利用

ブロー成型テーブル用 天板 価格(税抜)サイズ(mm)梱包才数梱包重量
CB-T-1845 23,500円 W1800×D450×H281.3才7.5kg
仕様/天板:樹脂ブロー成型品(28㎜厚) 入数:2(1個口)
樹脂製の天板なので水に濡れてもお手入れが簡単です。
色々な脚対応可能な樹脂天板。

樹脂テーブル(W1800×D450タイプ)
スライド脚


ブロー成型テーブル (スライド脚) 棚天板仕様価格(税抜)サイズ(mm) 梱包才数梱包重量
CBT-1845S 棚無し ブロー成型 42,000円 W1800×D450×H700 3.2才15kg
仕様/天板:樹脂ブロ-成型品 (t28mm) フレ-ム:スチ-ル (〼26mm) メラミン焼付塗装(シルバー/ ブラック) 入数:1 ●スライド脚 ●スタッキング可能 (天板合わせで25台まで)
バネ脚


ブロー成型テーブル (バネ脚) 棚天板仕様価格(税抜)サイズ(mm) 梱包才数梱包重量
CBT-1845B 棚無し ブロー成型 53,000円 W1800×D450×H700 3.2才15kg
仕様/天板:樹脂ブロ-成型品 (t28mm) フレ-ム:スチ-ル (〼26mm) メラミン焼付塗装(シルバー/
ブラック) 入数:1 ●バネ脚 ●スタッキング可能 (天板合わせで25台まで)
クランク脚


ブロー成型テーブル (クランク脚) 棚天板仕様価格(税抜)サイズ(mm) 梱包才数梱包重量
CBT-1845C 棚無し ブロー成型 50,000円 W1800×D450×H700 3.2才15kg
仕様/天板:樹脂ブロ-成型品 (t28mm) フレ-ム:スチ-ル (〼26mm) メラミン焼付塗装(シルバー/ ブラック) 入数:1 ●クランク脚 ●スタッキング可能 (天板合わせで25台まで)
薄型脚


ブロー成型テーブル (薄型脚) 棚天板仕様価格(税抜)サイズ(mm) 梱包才数梱包重量
CBT-1845U 棚無し ブロー成型 56,000円 W1800×D450×H700 3.2才14kg 仕様/天板:樹脂ブロ-成型品 (t28mm) フレ-ム:スチ-ル (〼26mm) メラミン焼付塗装(シルバー/
ブラック) 入数:1 ●薄型脚 ●スタッキング可能 (天板合わせで25台まで)
393 450 310 310 360 1800 20 アルミプレート 310 310 20 361 16 393 310 361 16 アルミプレートの 部分にテーブルの 貫フレームを組み付ける事ができます。 アルミプレート 天板裏面 393 450 310 310 360 1800 20 アルミプレート 310 310 20 361 16 393 310 361 16 アルミプレートの 部分にテーブルの 貫フレームを組み付ける事ができます。 アルミプレート 天板裏面
CB-T-1845
天板裏
CB-T-1845
CBT-1845S(BK)
CBT-1845S(SV)
CBT-1845C(BK)
CBT-1845C(SV)
CBT-1845B(BK)
CBT-1845B(SV)
CBT-1845U(BK)
CBT-1845U(SV)
372
樹脂薄型テーブル(W1800×D600タイプ)
チェアデスク・収納パーティションテーブルレセプションロビーエクステリアアクセサリー木工

BT-1860S
ブロー成型テーブル 棚天板仕様価格(税抜)サイズ(mm)梱包才数梱包重量
BT-1860S 棚無し ブロー成型 56,000円 W1800×D600×H700 2.9才15kg
仕様/天板:樹脂ブロ-成型品 (t54mm) フレ-ム:スチ-ル (〼26mm) メラミン焼付塗装 (シルバ-) 入数:1 ●脚間内寸:W1545×D392 ●スタッキング可能 (25台まで)
ブロー成型テーブル 棚 天板仕様価格(税抜)サイズ(mm)梱包才数梱包重量
BT-1860B 棚無し ブロー成型 56,000円 W1800×D600×H700 2.9才15kg
仕様/天板:樹脂ブロ-成型品 (t54mm) フレ-ム:スチ-ル (〼26mm) メラミン焼付塗装 (ブラック) 入数:1 ●脚間内寸:W1545×D392 ●スタッキング可能 (25台まで)
スタッキングの薄型化 スタッキング時のズレ防止

50mm
従来の折畳テーブルに比べて 約40mm薄くなりました。

天板の四隅にスタッキング用の溝 が設けてあり、スタッキング時にズ レない仕様になっています。
アルミ折畳み樹脂イス


ポリウレタン樹脂製のやわらかい クッションパット付き。

クッションパットは2重成型によって 内部に水が浸入しません。

BT-1860B
BT-1860B

スタッキング例
スタッキングをする際は、フラットな床面の上で、最大積載25台までとしてください。 過積載や不安定な場所での使用は、破損や歪みなどにつながる可能性がございます。



アルミ折畳みイス (クッションパット付) 価格(税抜) サイズ(mm) 梱包才数梱包重量
AFC-2APU 22,500円 W505×D450×H775 (SH415)4.0才17kg
仕様/背・座:樹脂成型品 クッション:ポリウレタン樹脂成型品 フレ-ム:アルミ (φ22mm) アルマイト仕上げ 入数:6 ●フラットスタッキング可能 ●屋外対応可能
幼保レンタル・リース
フラットスタッキング例 すっきりと収納できてスペースをとりません。
アルミ折畳みイス 価格(税抜) サイズ(mm) 梱包才数梱包重量
AFC-2A 17,300円 W505×D450×H775 (SH440)4.0才15.5kg
仕様/背・座:樹脂成型品 フレ-ム:アルミ (φ22mm) アルマイト仕上げ 入数:6
●フラットスタッキング可能 ●屋外対応可能
1800 1545 700 655 392 54 50 600 折り畳み時 21 9
373 SOCIA
合板芯折畳み薄型スチール脚テーブル
天板厚:t21mm 折畳時:H58mm






(シルバー脚) (ブラック脚) 棚 天板仕様価格(税抜)サイズ(mm) 梱包才数梱包重量
GTS-1860SSE GTS-1860BSE
GTS-1845SSE GTS-1845BSE
GTS-1260SSE GTS-1260BSE
GTS-1245SSE GTS-1245BSE
GTS-9060SSE GTS-9060BSE
GTS-9045SSE GTS-9045BSE
棚無し ソフトエッジ
合板芯折畳み薄型アルミ脚テーブル

59,000円 W1800×D600×H7004.2才 14kg
47,000円 W1800×D450×H7003.2才 12kg
58,000円 W1200×D600×H7002.8才 11kg
46,000円 W1200×D450×H7002.1才 9kg
57,000円 W900×D600×H7002.1才 10kg
45,000円 W900×D450×H7001.6才 8kg
仕様/天板:メラミン化粧板 (t21mm) 合板芯 フラッシュ加工 ソフトエッジ フレ-ム:スチ-ル (〼26mm) 入数:1 ●薄型脚 ●折畳時:H58mm (シルバー脚) (ブラック脚) 棚 天板仕様価格(税抜)サイズ(mm) 梱包才数梱包重量
GTS-A1860SSE GTS-A1860BSE
GTS-A1845SSE GTS-A1845BSE
GTS-A1260SSE GTS-A1260BSE
GTS-A1245SSE GTS-A1245BSE
仕様/天板:メラミン化粧板 (t21mm) 合板芯 フラッシュ加工

棚無し ソフトエッジ 59,000円 W1800×D600×H7004.2才 13kg
円 W1800×D450×H7003.2才 11kg
62,000円 W1200×D600×H7002.8才 10kg
55,000円 W1200×D450×H7002.1才 8kg
51,000
ソフトエッジ フレ-ム:アルミ (〼27mm) 入数:1 ●薄型脚 ●折畳時:H58mm
GTS-1860SSE(IV) GTS-1845BSE(TE)
GTS-9060BSE(RO)
GTS-A1860BSE(TE)
RO:ローズ TE:チーク IV:アイボリー ■カラーサンプル 374
GTS-A1845SSE(IV)
合板芯折畳み薄型スチール脚テーブル
天板厚:t27mm 折畳時:H64mm

GTA-1845SSE
GTA-9060SSE
GTA-9045SSE GTA-9045BSE



RO:ローズ TE:チーク IV:アイボリー


52,000円 W900×D600×H7002.1才 11kg
46,000円 W900×D450×H7001.6才 9kg
仕様/天板:メラミン化粧板 (t27mm) 合板芯 フラッシュ加工 ソフトエッジ フレ-ム:スチ-ル (〼26mm) 入数:1 ●薄型脚 ●折畳時:H64mm
合板芯折畳み薄型アルミ脚テーブル


幼保レンタル・リース
(シルバー脚) (ブラック脚) 棚 天板仕様価格(税抜)サイズ(mm) 梱包才数梱包重量 GTA-A1860SSE GTA-A1860BSE 棚無し ソフトエッジ 67,000円 W1800×D600×H7004.2才 14kg GTA-A1845SSE GTA-A1845BSE 60,000円 W1800×D450×H7003.2才 12kg GTA-A1260SSE GTA-A1260BSE 70,000円 W1200×D600×H7002.8才 11kg GTA-A1245SSE GTA-A1245BSE 63,000円 W1200×D450×H7002.1才 9kg 仕様/天板:メラミン化粧板 (t27mm) 合板芯 フラッシュ加工 ソフトエッジ フレ-ム:アルミ (〼27mm) 入数:1 ●薄型脚 ●折畳時:H64mm (シルバー脚) (ブラック脚) 棚 天板仕様価格(税抜)サイズ(mm) 梱包才数梱包重量
GTA-1860BSE 棚無し ソフトエッジ 65,000円
GTA-1860SSE
W1800×D600×H7004.2才 15kg
GTA-1845BSE 58,000
13kg
GTA-1260BSE 68,000
12kg
GTA-1245BSE 61,000
10kg
円 W1800×D450×H7003.2才
GTA-1260SSE
円 W1200×D600×H7002.8才
GTA-1245SSE
円 W1200×D450×H7002.1才
GTA-9060BSE
GTA-1860SSE(IV)
GTA-1845BSE(TE)
GTA-9060BSE(RO)
GTA-A1260SSE(IV)
GTA-A1245BSE(TE)
■カラーサンプル 375 SOCIA
チェアデスク・収納パーティションテーブルレセプションロビーエクステリアアクセサリー木工
上げ底天板テーブル
薄型脚

(シルバー脚) (ブラック脚)
AZT-1860SUAZT-1860BU
AZT-1845SUAZT-1845BU
AZT-1560SUAZT-1560BU
AZT-1545SUAZT-1545BU




棚天板仕様価格(税抜)サイズ(mm)梱包才数梱包重量
49,000円 W1800×D600×H7004.2才14kg
42,000円 W1800×D450×H7003.2才12kg

棚無し ソフトエッジ
48,000円 W1500×D600×H7003.5才11kg
42,000円 W1500×D450×H7002.6才10kg 仕様/天板:メラミン化粧板 (t21mm) 合板 ソフトエッジ フレ-ム:スチ-ル (〼26mm) 入数:1 ●薄型脚 ●折畳時:H58mm
スライド脚




(シルバー脚) (ブラック脚) 棚天板仕様価格(税抜)サイズ(mm)梱包才数梱包重量
AZT-1860SSAZT-1860BS
棚無し ソフトエッジ 40,000円 W1800×D600×H7004.2才14kg
仕様/天板:メラミン化粧板 (t21mm) 合板 ソフトエッジ フレ-ム:スチ-ル (〼26mm) 入数:1 ●スライド脚 ●折畳時:H84mm
※クランク脚・バネ脚も対応可能ですので、お気軽にお問い合わせ下さい。
AZT-1845SSAZT-1845BS
34,000円 W1800×D450×H7003.2才12kg
AZT-1860SU(IV)
天板裏
AZT-1845BU(TE)
AZT-1860BS(RO)
AZT-1845SS(RO)
AZT-1560BS(IV)
AZT-1845SS(IV)
RO:ローズ TE:チーク IV:アイボリー ■カラーサンプル 376
パネコートテーブル
チェアデスク・収納パーティションテーブルレセプションロビーエクステリアアクセサリー木工

パネコートテーブル 価格(税抜)サイズ(mm)梱包才数梱包重量 PNT-1860S
仕様/天板:パネコ-ト (t12mm) フレ-ム:スチ-ル (〼26mm) メラミン焼付塗装 入数:1 ●スライド脚 ●折畳時:H75mm


スタッキング例
ベニヤテーブル

ベニヤテーブル 価格(税抜)サイズ(mm)梱包才数梱包重量
仕様/天板:ベニヤ合板 (t12mm) フレ-ム:スチ-ル (〼26mm) メラミン焼付塗装 入数:1 ●スライド脚 ●折畳時:H75mm


スタッキング例
テーブル用オプション継脚



オプション継脚 価格(税抜) サイズ(mm)
OKT 3,300円
仕様/本体:スチ-ル (〼31mm) メラミン焼付塗装 ●2段階高さ調節 (H800/H900対応)
注意
テーブル脚の貫下寸法 A を ご確認ください。
テーブルの高さを+100mm にする場合には A の寸法が 276mm以上必要です。
幼保レンタル・リース
対応テーブル貫位置 A
テーブルの高さを+200mm にする場合には A の寸法が 174mm以上必要です。
アジャスターを外してテーブル脚を組み付ける場合には、 アジャスターを外した状態の A 寸法を確認してください。
27,000円 W1800×D600×H6804.2才 11kg
21,000円 W1800×D450×H6803.2才 10kg
PNT-1845S
32,000円 W1800×D600×H6804.2才 13kg
22,000円 W1800×D450×H6803.2才 11kg
VNT-1860
VNT-1845
〼31×H365
PNT-1860S
PNT-1845S
VNT-1860
OKT(GL) OKT(BK) OKT(SV)
VNT-1845
164 266 200 100 □26 貫下寸法 174 mm 以上 貫下寸法 276 mm 以上 貫 脚フレ ム
※ 377 SOCIA
折畳み会議テーブル
スライド脚




YKT-TN1845SSSE(IV)

YKT-TN1860BSSE(RO)
(シルバー脚) (シャンパンゴールド脚) (ブラック脚) 棚 天板仕様価格(税抜)サイズ(mm)梱包才数梱包重量 YKT-TN1890SSSEYKT-TN1890GSSEYKT-TN1890BSSE
YKT-TN1860SSSEYKT-TN1860GSSEYKT-TN1860BSSE
YKT-TN1845SSSEYKT-TN1845GSSEYKT-TN1845BSSE
棚無し ソフトエッジ
64,000円 W1800×D900×H700 ▲ 6.1才20kg
42,000円 W1800×D600×H7004.2才17kg
37,000円 W1800×D450×H7003.2才15kg 仕様/天板:メラミン化粧板 (t28mm) フラッシュ加工 ソフトエッジ フレ-ム:スチ-ル (〼26mm) メラミン焼付塗装 入数:1 ●スライド脚 ●折畳時:H91mm ※オプション継脚 P377参照
クランク脚


(シルバー脚) (シャンパンゴールド脚)
YKT-TN1260SCSEYKT-TN1260GCSEYKT-TN1260BCSE
YKT-TN1245SCSEYKT-TN1245GCSEYKT-TN1245BCSE
YKT-TN9090SCSEYKT-TN9090GCSEYKT-TN9090BCSE
YKT-TN9060SCSEYKT-TN9060GCSEYKT-TN9060BCSE
YKT-TN9045SCSEYKT-TN9045GCSEYKT-TN9045BCSE
W900×D900×H7003.1才14kg
41,000円 W900×D600×H7002.1才12kg
37,000円 W900×D450×H7001.6才11kg
仕様/天板:メラミン化粧板 (t28mm) フラッシュ加工 ソフトエッジ フレ-ム:スチ-ル (〼26mm) メラミン焼付塗装 入数:1 ●クランク脚 ●折畳時:H91mm ※オプション継脚 P377参照
棚 天板仕様価格(税抜)サイズ(mm)梱包才数梱包重量 YKT-TN1890SCSEYKT-TN1890GCSEYKT-TN1890BCSE 棚無し ソフトエッジ 58,000円 W1800×D900×H700 ▲ 6.1才20kg YKT-TN1860SCSEYKT-TN1860GCSEYKT-TN1860BCSE 43,000円 W1800×D600×H7004.2才17kg YKT-TN1845SCSEYKT-TN1845GCSEYKT-TN1845BCSE 38,000円 W1800×D450×H7003.2才15kg YKT-TN1560SCSEYKT-TN1560GCSEYKT-TN1560BCSE 43,000円 W1500×D600×H7003.5才14kg YKT-TN1545SCSEYKT-TN1545GCSEYKT-TN1545BCSE 38,000円 W1500×D450×H7002.6才11kg
(ブラック脚)
46,000円 W1200×D600×H7002.8才15kg
39,000円 W1200×D450×H7002.1才13kg
55,000円
RO:ローズ TE:チーク IV:アイボリー ■カラーサンプル 378
YKT-TN1890GCSE(IV) YKT-TN1560SCSE(RO)
バネ脚



RO:ローズ TE:チーク IV:アイボリー


(シルバー脚) (シャンパンゴールド脚) (ブラック脚) 棚 天板仕様価格(税抜)サイズ(mm)梱包才数梱包重量
YKT-TN1890SBSEYKT-TN1890GBSEYKT-TN1890BBSE
YKT-TN1860SBSEYKT-TN1860GBSEYKT-TN1860BBSE
円 W1800×D900×H700 ▲ 6.1才20kg
44,000円 W1800×D600×H7004.2才17kg
YKT-TN1845SBSEYKT-TN1845GBSEYKT-TN1845BBSE 39,000円 W1800×D450×H7003.2才15kg
YKT-TN1560SBSEYKT-TN1560GBSEYKT-TN1560BBSE
YKT-TN1545SBSEYKT-TN1545GBSEYKT-TN1545BBSE
YKT-TN1260SBSEYKT-TN1260GBSEYKT-TN1260BBSE
YKT-TN1245SBSEYKT-TN1245GBSEYKT-TN1245BBSE
YKT-TN9090SBSEYKT-TN9090GBSEYKT-TN9090BBSE
YKT-TN9060SBSEYKT-TN9060GBSEYKT-TN9060BBSE
YKT-TN9045SBSEYKT-TN9045GBSEYKT-TN9045BBSE
47,000円 W1200×D600×H7002.8才15kg
40,000円 W1200×D450×H7002.1才13kg
56,000円 W900×D900×H7003.1才14kg
42,000円 W900×D600×H7002.1才12kg
38,000円 W900×D450×H7001.6才11kg 仕様/天板:メラミン化粧板 (t28mm) フラッシュ加工 ソフトエッジ フレ-ム:スチ-ル (〼26mm) メラミン焼付塗装 入数:1 ●バネ脚 ●折畳時:H91mm ※オプション継脚 P377参照
薄型脚


幼保レンタル・リース
仕様/天板:メラミン化粧板 (t28mm) フラッシュ加工 ソフトエッジ フレ-ム:スチ-ル (〼26mm) メラミン焼付塗装 入数:1 ●薄型脚 ●折畳時:H65mm ※オプション継脚 P377参照
棚無し ソフトエッジ 59,000
44,000円 W1500×D600×H7003.5才14kg
39,000円 W1500×D450×H7002.6才11kg
(シルバー脚) (ブラック脚) 棚 天板仕様価格(税抜) サイズ(mm) 梱包才数梱包重量 YKT-TN1860SUSEYKT-TN1860BUSE 棚無し ソフトエッジ 50,000円 W1800×D600×H7004.2才 17kg YKT-TN1845SUSEYKT-TN1845BUSE 44,000円 W1800×D450×H7003.2才 15kg YKT-TN1560SUSEYKT-TN1560BUSE 50,000円 W1500×D600×H7003.5才 14kg YKT-TN1545SUSEYKT-TN1545BUSE 43,000円 W1500×D450×H7002.6才 11kg YKT-TN1260SUSEYKT-TN1260BUSE 57,000円 W1200×D600×H7002.8才 15kg YKT-TN1245SUSEYKT-TN1245BUSE 52,000円 W1200×D450×H7002.1才 13kg YKT-TN9060SUSEYKT-TN9060BUSE 52,000円 W900×D600×H7002.1才 12kg YKT-TN9045SUSEYKT-TN9045BUSE 44,000円 W900×D450×H7001.6才 11kg
YKT-TN9045BBSE(TE)
YKT-TN1260SBSE(TE)
YKT-TN9060BUSE(RO)
YKT-TN1260SUSE(IV)
■カラーサンプル 379 SOCIA
チェアデスク・収納パーティションテーブルレセプションロビーエクステリアアクセサリー木工
抗ウイルス折畳み会議テーブル
スライド脚

VKT-TN1845SSSE(WH)
VKT-1860BSSE(NA)


WH:ホワイト NA:ナチュラル ■抗ウイルス天板カラーサンプル

(シルバー脚) (シャンパンゴールド脚) (ブラック脚) 棚 天板仕様価格(税抜)サイズ(mm)梱包才数梱包重量
VKT-TN1890SSSEVKT-TN1890GSSEVKT-TN1890BSSE
VKT-TN1860SSSEVKT-TN1860GSSEVKT-TN1860BSSE
VKT-TN1845SSSEVKT-TN1845GSSEVKT-TN1845BSSE
棚無し ソフトエッジ
95,000円 W1800×D900×H700 ▲ 6.1才20kg
80,000円 W1800×D600×H7004.2才17kg
57,000円 W1800×D450×H7003.2才15kg
仕様/天板:抗ウイルスメラミン化粧板 (t28mm) フラッシュ加工 抗ウイルスソフトエッジ 天板裏:抗ウイルスバッカ- フレ-ム:スチ-ル (〼26mm) メラミン焼付塗装 入数:1 ●スライド脚 ●折畳時:H91mm ※オプション継脚 P377参照
クランク脚

VKT-TN1890GCSE(WH)
(シルバー脚) (シャンパンゴールド脚) (ブラック脚)

VKT-TN1560SCSE(WH)
VKT-TN1260SCSEVKT-TN1260GCSEVKT-TN1260BCSE
VKT-TN1245SCSEVKT-TN1245GCSEVKT-TN1245BCSE
VKT-TN9090SCSEVKT-TN9090GCSEVKT-TN9090BCSE
VKT-TN9060SCSEVKT-TN9060GCSEVKT-TN9060BCSE
VKT-TN9045SCSEVKT-TN9045GCSEVKT-TN9045BCSE
W900×D900×H7003.1才14kg
70,000円 W900×D600×H7002.1才12kg
44,000円 W900×D450×H7001.6才11kg
仕様/天板:抗ウイルスメラミン化粧板 (t28mm) フラッシュ加工 抗ウイルスソフトエッジ 天板裏:抗ウイルスバッカ- フレ-ム:スチ-ル (〼26mm) メラミン焼付塗装 入数:1 ●クランク脚 ●折畳時:H91mm ※オプション継脚 P377参照
棚 天板仕様価格(税抜)サイズ(mm)梱包才数梱包重量 VKT-TN1890SCSEVKT-TN1890GCSEVKT-TN1890BCSE 棚無し ソフトエッジ 94,000円 W1800×D900×H700 ▲ 6.1才20kg VKT-TN1860SCSEVKT-TN1860GCSEVKT-TN1860BCSE 79,000円 W1800×D600×H7004.2才17kg VKT-TN1845SCSEVKT-TN1845GCSEVKT-TN1845BCSE 56,000円 W1800×D450×H7003.2才15kg VKT-TN1560SCSEVKT-TN1560GCSEVKT-TN1560BCSE 75,000円 W1500×D600×H7003.5才14kg VKT-TN1545SCSEVKT-TN1545GCSEVKT-TN1545BCSE 54,000円 W1500×D450×H7002.6才11kg
62,000円 W1200×D600×H7002.8才15kg
56,000円 W1200×D450×H7002.1才13kg
85,000円
380
バネ脚
チェアデスク・収納パーティションテーブルレセプションロビーエクステリアアクセサリー木工

VKT-TN1260BBSE(WH)

(シルバー脚) (シャンパンゴールド脚) (ブラック脚) 棚 天板仕様価格(税抜)サイズ(mm)梱包才数梱包重量
VKT-TN1860SBSEVKT-TN1860GBSEVKT-TN1860BBSE
VKT-TN1845SBSEVKT-TN1845GBSEVKT-TN1845BBSE
VKT-TN1560SBSEVKT-TN1560GBSEVKT-TN1560BBSE
VKT-TN1545SBSEVKT-TN1545GBSEVKT-TN1545BBSE
VKT-TN1890SBSEVKT-TN1890GBSEVKT-TN1890BBSE 棚無し ソフトエッジ
VKT-TN1260SBSEVKT-TN1260GBSEVKT-TN1260BBSE
VKT-TN1245SBSEVKT-TN1245GBSEVKT-TN1245BBSE
VKT-TN9090SBSEVKT-TN9090GBSEVKT-TN9090BBSE
VKT-TN9060SBSEVKT-TN9060GBSEVKT-TN9060BBSE
VKT-TN9045SBSEVKT-TN9045GBSEVKT-TN9045BBSE
薄型脚

VKT-TN1260SUSE(WH)
95,000円 W1800×D900×H700 ▲ 6.1才20kg
80,000円 W1800×D600×H7004.2才17kg
57,000円 W1800×D450×H7003.2才15kg
76,000円 W1500×D600×H7003.5才14kg
55,000円 W1500×D450×H7002.6才11kg
69,000円 W900×D900×H7003.1才14kg
54,000円 W900×D600×H7002.1才12kg
45,000円 W900×D450×H7001.6才11kg
仕様/天板:抗ウイルスメラミン化粧板 (t28mm) フラッシュ加工 抗ウイルスソフトエッジ 天板裏:抗ウイルスバッカ- フレ-ム:スチ-ル (〼26mm) メラミン焼付塗装 入数:1 ●バネ脚 ●折畳時:H91mm ※オプション継脚 P377参照 (シルバー脚) (ブラック脚) 棚 天板仕様価格(税抜)サイズ(mm)梱包才数梱包重量
VKT-TN1860SUSE VKT-TN1860BUSE

幼保レンタル・リース
VKT-TN9045SUSE VKT-TN9045BUSE
円 W900×D450×H7001.6才11kg 仕様/天板:抗ウイルスメラミン化粧板 (t28mm) フラッシュ加工 抗ウイルスソフトエッジ 天板裏:抗ウイルスバッカ- フレ-ム:スチ-ル (〼26mm) メラミン焼付塗装 入数:1 ●薄型脚 ●折畳時:H65mm ※オプション継脚 P377参照
63,000円 W1200×D600×H7002.8才15kg
57,000
円 W1200×D450×H7002.1才13kg
棚無し ソフトエッジ 86,000円 W1800×D600×H7004.2才17kg VKT-TN1845SUSE VKT-TN1845BUSE 62,000円 W1800×D450×H7003.2才15kg VKT-TN1560SUSE VKT-TN1560BUSE 82,000円 W1500×D600×H7003.5才14kg VKT-TN1545SUSE VKT-TN1545BUSE 60,000円 W1500×D450×H7002.6才11kg VKT-TN1260SUSE VKT-TN1260BUSE 72,000円 W1200×D600×H7002.8才15kg VKT-TN1245SUSE VKT-TN1245BUSE 58,000円 W1200×D450×H7002.1才13kg VKT-TN9060SUSE VKT-TN9060BUSE 71,000円 W900×D600×H7002.1才12kg
49,000
VKT-TN9045SBSE(NA)
381 SOCIA
VKT-TN9060BUSE(NA)

一体型成型エッジ天板 天板とエッジの密着が強固で、水分が 天板内部に侵入しにくいことから水のか かる環境に対しても比較的強い特徴が あります。(耐、防水構造ではありません)

(シルバー脚) (ブラック脚)
SO-1860S SO-1860B
SO-1845S SO-1845B
一体成型天板テーブル スライド脚 バネ脚


棚 天板仕様価格(税抜)サイズ(mm) 梱包才数梱包重量
棚無し 一体成型エッジ 67,000円 W1800×D600×H7004.2才 15kg
54,000円 W1800×D450×H7003.2才 14kg
仕様/天板:メラミン化粧板 (t26mm) フラッシュ加工 ウレタン一体成型エッジ フレ-ム:スチ-ル (〼26mm) メラミン焼付塗装 入数:1 ●スライド脚 ●折畳時:H90mm

(シルバー脚) (ブラック脚)
SO-1860SB SO-1860BB

棚 天板仕様価格(税抜)サイズ(mm) 梱包才数梱包重量
棚無し 一体成型エッジ 70,000円 W1800×D600×H7004.2才 15kg
SO-1845SB SO-1845BB 57,000円 W1800×D450×H7003.2才 14kg 仕様/天板:メラミン化粧板 (t26mm) フラッシュ加工 ウレタン一体成型エッジ フレ-ム:スチ-ル (〼26mm) メラミン焼付塗装 入数:1 ●バネ脚 ●折畳時:H90mm
薄型ワイド脚

(シルバー脚) (ブラック脚)
STO-1860 STO-1860B
STO-1845 STO-1845B

棚 天板仕様価格(税抜)サイズ(mm) 梱包才数梱包重量
棚無し 一体成型エッジ 82,000円 W1800×D600×H7004.2才 16kg
73,000円
仕様/天板:メラミン化粧板
ウレタン一体成型エッジ フレ-ム:スチ-ル
メラミン焼付塗装 入数:1 ●薄型ワイド脚
W1800×D450×H7003.2才 14kg
(t26mm) フラッシュ加工
(〼26mm)
●折畳時:H66mm ●ワンタッチロック式脚
SO-1860S(TE)
SO-1845B(TE)
SO-1860BB(TE)
SO-1845SB(TE)
STO-1860(TE)
■天板色 382
STO-1845B(TE) TE:チーク
アルミ高さ調節脚テーブル
H700~950タイプ
シルバー脚
チェアデスク・収納パーティションテーブルレセプションロビーエクステリアアクセサリー木工

H700mm時 OTC-1860SSE(TE)
昇降機能付アルミ折畳会議テーブル 棚天板仕様価格(税抜)サイズ(mm)梱包才数梱包重量
OTC-1860SOTC-1860B 棚無し ソフトエッジ
OTC-1845SOTC-1845B
■天板色


RO:ローズ TE:チーク

IV:アイボリー
ブラック脚

H950mm時 OTC-1845BSE(IV)
76,000円 W1800×D600× H700~950 4.2才14kg
68,000円 W1800×D450× H700~950 3.2才13kg
仕様/天板:メラミン化粧板 (t28mm) フラッシュ加工 ソフトエッジ フレ-ム:アルミ (〼27mm) 粉体塗装 (シル バ-・ブラック) 調節部脚:アルミ (〼23.5mm) 入数:1 ●5段階 (50mmピッチ) で高さ調節が可能です。 ●折畳時:H91mm


OTC-1860/1845 脚短縮 脚延長
スチール高さ調節脚テーブル
H700~900タイプ


昇降機能付 折畳み会議テーブル 棚天板仕様価格(税抜) サイズ(mm) 梱包才数梱包重量
KG-1860
KG-1845
72,000円 W1800×D600×H700~9004.2才16kg
■天板色

IV:アイボリー


RO:ローズ TE:チーク


高さ調節イメージ 4段階(50㎜ピッチ)で 高さ調節が可能です。
幼保レンタル・リース
棚無し ソフトエッジ
61,000円 W1800×D450×H700~9003.2才15kg 仕様/天板:メラミン化粧板 (t28mm) フラッシュ加工 ソフトエッジ フレ-ム:スチ-ル (〼28mm) メラミン焼付塗装 調節部脚:(〼26mm) クロ-ムメッキ 入数:1 ●4段階 (50mmピッチ) で高さ調節が可能です。 ●天板が (RO) (TE) のフレ-ムカラ-はシャンパンゴ-ルド、(IV) のフレ-ムカラ-はシルバ-で す。 ● (RO) (TE) の天板は黒、(IV) の天板は白のソフトエッジになります。 ●折畳時:H91.5mm
KG-1860・KG-1845
600/ 450 1800 1695 645 ~ 845 700 ~ 900 92 折り畳み時 447/ 345 600/ 450 1800 1675 700 ~ 950 645 ~ 895 91 折り畳み時
KG-1845(TE)
脚短縮 脚延長
383 SOCIA
抗ウイルスカフェテーブル
ラウンド脚


SI-5050(NA)+ROU-4060T(BK)

SI-4545(DBR)+ROU-3676M

SI-6565(WH)+ROU-4560T(SV)
■脚カラーサンプル


クロームメッキ シルバー ブラック

品番 ベース 支柱 カラー
価格(税抜)サイズ(mm)梱包才数梱包重量

MR-750(NA)+ROU-4560T(SV)

MR-550(DBR)+ROU-3676M

MR-650(WH)+ROU-4060T(BK)
品番 ベース 支柱 カラー
価格(税抜)サイズ(mm)梱包才数梱包重量
■天板カラーサンプル


WH:ホワイト NA:ナチュラル DBR:ダークブラウン

天板 仕様 品番サイズ(mm)価格(税抜)梱包才数梱包重量
◯ MR-850 φ850 43,000円 1.1才10kg
□ SI-7575 〼750 38,000円 0.9才9kg
◯ MR-800 φ800 42,500円 1.0才8kg
□ SI-7070 〼700 37,000円 0.7才6kg
天板 仕様 品番サイズ(mm)価格(税抜)梱包才数梱包重量
◯ MR-750 φ750 42,500円 0.9才7kg
□ SI-6565 〼650 37,000円 0.7才5kg
天板 仕様 品番サイズ(mm)価格(税抜)梱包才数梱包重量
◯ MR-650 φ650 42,000円 0.7才5kg
□ SI-5050 〼500 28,000円 0.4才4.5kg
天板 仕様 品番サイズ(mm)価格(税抜)梱包才数梱包重量
◯ MR-550 φ550 32,000円 0.5才4kg
ROU-3676T(BK/SV)
ROU-3660M
ROU-3660T(BK/SV)
φ360
仕様/脚・支柱:スチ-ル クロ-ムメッキ/粉体塗装 (ブラック・シルバ-) ベ-ス:スチ-ル クロ-ムメッキ/粉体塗装 (ブラック・シルバ-)
□ SI-4545 〼450 22,000円 0.3才3kg
仕様/抗ウイルスメラミン化粧板 (t28mm) 抗ウイルスABSエッジ 天板裏:抗ウイルスバッカ-
脚 天板
ROU-5076M φ500 φ76 クロ-ムメッキ 68,000円 φ500×H672 2.4才10kg ROU-5076T(BK/SV) 粉体塗装 58,000円 ROU-5060M φ60 クロ-ムメッキ 64,000円 2.4才9.5kg ROU-5060T(BK/SV) 粉体塗装 54,000円
ROU-4576M φ450 φ76 クロ-ムメッキ 63,000円 φ450×H672 2.1才9kg ROU-4576T(BK/SV) 粉体塗装 54,000円 ROU-4560M φ60 クロ-ムメッキ 58,000円 2.1才8kg ROU-4560T(BK/SV) 粉体塗装 50,000円 品番 ベース 支柱 カラー 価格(税抜)サイズ(mm)梱包才数梱包重量 ROU-4076M φ400 φ76 クロ-ムメッキ 58,000円 φ400×H672 2.1才7.5kg ROU-4076T(BK/SV) 粉体塗装 50,000円 ROU-4060M φ60 クロ-ムメッキ 54,000円 2.1才7kg ROU-4060T(BK/SV) 粉体塗装 46,000円
カラー
品番 ベース 支柱
価格(税抜)サイズ(mm)梱包才数梱包重量 ROU-3676M
φ76 クロ-ムメッキ 56,000円 φ360×H672 2.1才6.5kg
粉体塗装 47,000円
φ60 クロ-ムメッキ 52,000円 2.1才6kg
粉体塗装 44,000
円
ROU-4560T(SV)
384
抗ウイルスカフェテーブル クロス脚
チェアデスク・収納パーティションテーブルレセプションロビーエクステリアアクセサリー木工


SI-7575(WH)+JEE-6638T(BK)

SI-8585(NA)+JEE-7638T(SV)

SI-7575(DBR)+JEE-6638M
■脚カラーサンプル




MR-850(WH)+JEE-6638T(BK)

MR-850(NA)+JEE-6638M

MR-900(DBR)+JEE-7638T(SV)
■天板カラーサンプル



WH:ホワイト NA:ナチュラル DBR:ダークブラウン
脚 天板
品番 ベース 支柱 カラー
価格(税抜)サイズ(mm)梱包才数梱包重量
JEE-7638M 760 φ38 クロ-ムメッキ 45,000円 W760×D760× H672 3.2才6kg JEE-7638T(BK/SV)
品番 ベース 支柱 カラー
価格(税抜)サイズ(mm)梱包才数梱包重量
JEE-6638M 660 φ38 クロ-ムメッキ 44,000円 W660×D660× H672 2.4才5kg
JEE-6638T(BK/SV)
品番 ベース 支柱 カラー
円
価格(税抜)サイズ(mm)梱包才数梱包重量
JEE-6138M 610 φ38 クロ-ムメッキ 44,000円 W610×D610× H672 2.4才4.5kg
JEE-6138T(BK/SV)
品番 ベース 支柱 カラー
39,000円
価格(税抜)サイズ(mm)梱包才数梱包重量
クロ-ムメッキ/粉体塗装 (ブラック・シルバ-) ベ-ス:スチ-ル クロ-ムメッキ/粉体塗装 (ブラック・シルバ-)
天板 仕様 品番サイズ(mm)価格(税抜)梱包才数梱包重量
◯ MR-900 φ900
□ SI-8585 〼850
43,000円 1.2才12kg
38,000円 1.1才11kg
天板 仕様 品番サイズ(mm)価格(税抜)梱包才数梱包重量
◯ MR-850 φ850
□ SI-7575 〼750
43,000円 1.1才10kg
38,000円 0.9才9kg
天板 仕様 品番サイズ(mm)価格(税抜)梱包才数梱包重量
◯ MR-800 φ800 42,500円 1.0才8kg
□ SI-7070 〼700 37,000円 0.7才6kg
天板 仕様 品番サイズ(mm)価格(税抜)梱包才数梱包重量
◯ MR-750 φ750 42,500円 0.9才7kg
□ SI-6565 〼650 37,000円 0.7才5kg
仕様/抗ウイルスメラミン化粧板 (t28mm) 抗ウイルスABSエッジ 天板裏:抗ウイルスバッカ-
幼保レンタル・リース
粉体塗装 40,000円
粉体塗装 39,000
粉体塗装
JEE-5638M 560 φ38 クロ-ムメッキ 44,300円 W560×D560× H672 2.2才4kg JEE-5638T(BK/SV) 粉体塗装 39,000円 仕様/脚・支柱:スチ-ル
シルバー
クロームメッキ
ブラック
JEE-6638M
385 SOCIA
抗ウイルスカフェテーブル
ラッパ脚


SI-5555(NA)+RYS-4038T(BK)

SI-6060(WH)+RYS-4538M
■脚カラーサンプル




MR-700(NA)+RYS-4538M

MR-650(DBR)+RYS-4038T(BK)
■天板カラーサンプル



脚 天板
品番 ベース 支柱 カラー
RYS-4538M
価格(税抜)サイズ(mm)梱包才数梱包重量
φ450 φ38 クロ-ムメッキ 44,000円 φ450×H6722.1才6kg
RYS-4538T(BK/SV) 粉体塗装 37,000円
品番 ベース 支柱 カラー
RYS-4038M
価格(税抜)サイズ(mm)梱包才数梱包重量
φ400 φ38 クロ-ムメッキ 40,000円 φ400×H6722.1才5kg
RYS-4038T(BK/SV) 粉体塗装 35,000円
品番 ベース 支柱 カラー
RYS-3638M
価格(税抜)サイズ(mm)梱包才数梱包重量
φ360 φ38 クロ-ムメッキ 39,000円
RYS-3638T(BK/SV) 粉体塗装 34,000円 仕様/脚・支柱:スチ-ル クロ-ムメッキ/粉体塗装 (ブラック・シルバ-) ベ-ス:スチ-ル クロ-ムメッキ/粉体塗装 (ブラック・シルバ-)
φ360×H6722.1才4kg
天板 仕様 品番サイズ(mm)価格(税抜)梱包才数梱包重量 ◯ MR-700 φ700 42,000円 0.8才6kg
□ SI-6060 〼600 29,000円 0.6才5kg
天板 仕様 品番サイズ(mm)価格(税抜)梱包才数梱包重量 ◯ MR-650 φ650 42,000円 0.7才5kg
□ SI-5555 〼550 28,000円 0.5才4kg
天板 仕様 品番サイズ(mm)価格(税抜)梱包才数梱包重量
◯ MR-450 φ450 27,000円 0.3才3kg
□ SI-4545 〼450 22,000円 0.3才3kg
仕様/抗ウイルスメラミン化粧板 (t28mm) 抗ウイルスABSエッジ 天板裏:抗ウイルスバッカ-
WH:ホワイト NA:ナチュラル
DBR:ダークブラウン
シルバー
クロームメッキ
ブラック
RYS-4038T(BK)
386
抗ウイルスカフェテーブル
昇降式ラウンド脚
チェアデスク・収納パーティションテーブルレセプションロビーエクステリアアクセサリー木工

RSC-5060M

SI-6060(WH)+RSC-4560M

SI-7070(DBR)+RSC-5060M(高さ調整時)


MR-750(NA)+RSC-5060MMR-750(NA)+RSC-5060M(高さ調整時)



※インナーパイプには メモリが刻まれています。



脚昇降・施錠 脚昇降・解錠 昇降メモリ
■天板カラーサンプル クロームメッキ シルバー ブラック ■脚カラーサンプル ※インナーパイプはクロームメッキになります。
品番 ベース 支柱 カラー
価格(税抜)サイズ(mm)梱包才数梱包重量



DBR:ダークブラウン
品番 ベース 支柱 カラー
RSC-4560T(BK/SV)
品番 ベース 支柱 カラー
RSC-4060M
価格(税抜)サイズ(mm)梱包才数梱包重量
価格(税抜)サイズ(mm)梱包才数梱包重量
φ400 φ60 クロ-ムメッキ 68,000円
RSC-4060T(BK/SV) 粉体塗装 61,000円 仕様/脚・支柱:スチ-ル クロ-ムメッキ/粉体塗装 (ブラック・シルバ-) ベ-ス:スチ-ル クロ-ムメッキ/粉体塗装 (ブラック・シルバ-) ●昇降機能付 (H675~H975mm)
2.1才9kg
天板 仕様 品番サイズ(mm)価格(税抜)梱包才数梱包重量
◯ MR-750 φ750 42,500円 0.9才7kg
□ SI-7070 〼700 37,000円 0.7才6kg
天板 仕様 品番サイズ(mm)価格(税抜)梱包才数梱包重量
◯ MR-700 φ700 42,000円 0.8才6kg
□ SI-6060 〼600 29,000円 0.6才5kg
天板 仕様 品番サイズ(mm)価格(税抜)梱包才数梱包重量
◯ MR-650 φ650 42,000円 0.7才5kg
□ SI-5050 〼500 28,000円 0.4才4.5kg 仕様/抗ウイルスメラミン化粧板 (t28mm) 抗ウイルスABSエッジ 天板裏:抗ウイルスバッカ- WH:ホワイト
幼保レンタル・リース
脚 天板
RSC-5060M φ500 φ60 クロ-ムメッキ 77,000円 φ500× H675~975 2.4才11kg
粉体塗装 68,000
RSC-5060T(BK/SV)
円
クロ-ムメッキ
円 φ450× H675~975 2.1才10kg
RSC-4560M φ450 φ60
72,000
粉体塗装 64,000
円
φ400× H675~975
NA:ナチュラル
387 SOCIA
組立式ユニットカウンター
H900


BK:ブラック WH:ホワイト



UNC-H1570T(BK) 212,000円 W1500×D700×H9005.6才33kg
UNC-H1570T(WH)
UNC-H1260T(BK) 170,000円 W1200×D600×H9004.3才28kg
UNC-H1260T(WH) 158,000円 W1200×D600×H9004.3才28kg
仕様/天板:メラミン化粧板 側板・幕板・棚板:ポリ化粧板 エッジ:メラミン化粧板 入数:1(3個口)
組立手順
①幕板取付②棚板取付③天板取付④完成


H700





組立式ユニットカウンター 価格(税抜)サイズ(mm)梱包才数梱包重量
UNC-L1870T(BK) 236,000円 W1800×D700×H700 ▲ 7.2才35kg
UNC-L1870T(WH) 226,000円 W1800×D700×H700 ▲ 7.2才35kg
UNC-L1570T(BK) 244,000円 W1500×D700×H7005.6才31kg
UNC-L1570T(WH) 216,000円 W1500×D700×H7005.6才31kg
UNC-L1260T(BK) 180,000円 W1200×D600×H7004.3才26kg
UNC-L1260T(WH) 162,000円 W1200×D600×H7004.3才26kg
仕様/天板:メラミン化粧板 側板・幕板・棚板:ポリ化粧板 エッジ:メラミン化粧板 入数:1(3個口)
700 4132 11 1200 600 1098 550 250137 700 4132 11 1500 700 1398 650 300137 700 4132 11 1800 700 1698 650 300137 900 6132 11 1200 600 1098 550 350137 900 6132 11 1500 700 1398 650 400137 900 6132 11 1800 700 1698 650 400137 組立式ユニットカウンター 価格(税抜)サイズ(mm) 梱包才数梱包重量 UNC-H1870T(BK) 230,000円 W1800×D700×H900 ▲ 7.2才 ▲ 37kg UNC-H1870T(WH) 210,000円 W1800×D700×H900 ▲ 7.2才 ▲ 37kg
193,000円 W1500×D700×H9005.6才33kg
UNC-H1870T
UNC-H1570T
UNC-H1260T)
UNC-L1870T(WH)
UNC-L1570T(WH)
UNC-L1260T(BK)
UNC-L1260T(BK)
UNC-L1570T(WH)
UNC-L1870T(WH)
■カラーサンプル
UNC-H1870T(WH)
UNC-H1570T(WH)
388
UNC-H1260T(BK)
折畳み受付カウンター
チェアデスク・収納パーティションテーブルレセプションロビーエクステリアアクセサリー木工


組立手順 ① ② ③ ④





BK:ブラック WH:ホワイト


折畳み受付カウンター 価格(税抜) サイズ(mm) 梱包才数梱包重量
UC-900(BK) 145,000円 W900×D450×H900 3.2才 18kg
UC-900(WH) 134,000円 W900×D450×H900 3.2才 18kg
仕様/天板:メラミン化粧板 本体:ポリ化粧合板 エッジ:メラミン化粧板 入数:1(2個口)
スタンドカウンター



スタンドカウンター 価格(税抜) サイズ(mm) 梱包才数梱包重量
SCT-6545(BK) 210,000円 W600×D450×H90010.0才 22kg
SCT-6545(WH) 200,000円 W600×D450×H90010.0才 22kg
仕様/天板:メラミン化粧板 本体:ポリ化粧合板 エッジ:メラミン化粧板 入数:1 ●鍵付 ●アジャスタ-付

幼保レンタル・リース
 UC-900(BK)
UC-900(WH)
UC-900(WH) 中棚付
SCT-6545(BK)
UC-900(BK)
UC-900(WH)
UC-900(WH) 中棚付
SCT-6545(BK)
鍵付
SCT-6545(WH) 収納イメージ
■カラーサンプル 389 SOCIA
折畳みイス
SFC-2T


折畳みイス 価格(税抜) サイズ(mm)梱包才数梱包重量
SFC-2T 8,100円 W450×D470×H765 (SH440) 3.7才20kg
仕様/張地:合成皮革 (ポリウレタンレザ-) フレ-ム:スチ-ルパイプ (φ22.2mm) 粉体塗装 (シルバ-) 入数:4 ●シリンダ-式折畳み機構
SFC-2背(パーツ部品)


樹脂折畳みイス

SFC-2用背板 価格(税抜)
SFC-2BS オープン
仕様/ 入数:1
SFC-2M




折畳みイス 価格(税抜) サイズ(mm)梱包才数梱包重量
SFC-2M 10,700円 W450×D470×H765 (SH440) 3.7才20kg 仕様/張地:合成皮革 (ポリウレタンレザ-) フレ-ム:スチ-ルパイプ (φ22.2mm) クロ-ムメッキ 入数:4 ●シリンダ-式折畳み機構
SFC-2座(パーツ部品)





折畳みイス 価格(税抜) サイズ(mm)梱包才数梱包重量
FP-930 12,000円 W480×D510×H770 (SH425) 4.1才21.2kg 仕様/背・座:樹脂成型品 フレ-ム:スチ-ル 粉体塗装 入数:5 ●フラットスタッキング可能 ●シリンダ-式折畳み機構
※チェア台車はP109をご参照下さい。
SFC-2用座板 価格(税抜)
SFC-2ST オープン
仕様/ 入数:1
レセプションチェア/台車



レセプションチェア 価格(税抜) サイズ(mm)梱包才数梱包重量 MMR-2M 51,000円 W465×D535×H815 (SH445)15.0才 ▲ 30kg 仕様/張地:PVC フレ-ム:スチ-ル クロ-ムメッキ 入数:5
レセプションチェア 価格(税抜) サイズ(mm)梱包才数梱包重量 MMR-2HM 53,000円 W465×D550×H910 (SH445)15.0才29kg
仕様/張地:PVC フレ-ム:スチ-ル クロ-ムメッキ 入数:4
チェア台車 価格(税抜)サイズ(mm)梱包才数梱包重量 MMP-73 42,000円 W530×D580×H1251.8才4.8kg 仕様/脚部:φ50mmキャスタ-付 (ストッパ-付2個) 入数:1 ●最大積載数8脚まで ●対応機種:MMR-2HM、MMR-2M
440 390 (座) 480 510 935 770 41 5 31 112112 折り畳み/ スタッキング
SFC-2T(BL) SFC-2T(BR) SFC-2M(BL) SFC-2M(BR)
SFC-2BS(BL)
SFC-2BS(BR)
SFC-2ST(BL)
SFC-2ST(BR)
FP-930(BK)
スタッキング例
折り畳み機構 折畳み部はシリンダー機構で、指 挟みしにくい構造です。
連結 隣結同士のチェアを簡単に連結 できます。
■カラーサンプル
BR:ブラウン BL:ブルー
390
MMR-2M MMR-2HM MMP-73
スタッキングチェア
チェアデスク・収納パーティションテーブルレセプションロビーエクステリアアクセサリー木工

MK-480(BK)

MK-480(WH)
マッキンリー 価格(税抜) サイズ(mm)梱包才数梱包重量
MK-480 25,800円 W485×D530×H745 (SH400)9.9才21kg 仕様/張地:合成皮革 脚:スチ-ル (φ13mm) クロ-ムメッキ 入数:4 ●スタッキング可能 (4脚まで) ●連結仕様も対応可能です
※台車は P109 をご参照下さい。


MK-480背(パーツ部品)


マッキンリーレザー 背表 価格(税抜)
MACZB オープン 仕様/ 入数:1
マッキンリーレザー 背裏 価格(税抜) MACZC オープン 仕様/ 入数:1
オプションメモ台


スタッキング例

MK-480 連結仕様も対応可能です。 ※別途お見積もりいたします。

MK-480座(パーツ部品)


マッキンリーレザー 座 価格(税抜) MACZA オープン 仕様/ 入数:1


幼保レンタル・リース



ソフトエッジ フレ-ム:アルミ 粉体塗装 (シルバ-) ●対応パイプ径:φ12.7㎜・φ13㎜ 入数:2
400 745 530 845 630 485 420 (座) 430 スタッキング/ 4脚
メモ台 棚天板仕様価格(税抜)サイズ(mm) 梱包才数梱包重量 MEO-305 棚無し ソフトエッジ 45,000円 W95~305×D310× H680~900 3.0才9.8kg
仕様/天板:低圧メラミン化粧板
MACZB(BK) ブラック
MACZB(WH) ホワイト
MACZA(BK) ブラック
MACZA(WH) ホワイト
MEO-305 + MK-480(BK)
ロックレバー 脚フレームにしっかり 固定できます。 位置調節 ダイヤルでメモ台の位置を 調整可能。 荷掛け
MEO-305 + MK-480(BK) 跳ね上げ時
※対応パイプ径φ12.7mm・φ13mm
WH:ホワイト BK:ブラック
391 SOCIA
■カラーサンプル
ミーティングチェア
SC-20








ミーティングチェア 価格(税抜) サイズ(mm)梱包才数梱包重量
SC-20 15,400円 W440×D450×H775 (SH440)6.5才13kg
仕様/背・座:樹脂成型品 フレ-ム:スチ-ル (φ19.1mm) クロ-ムメッキ 入数:4 ●スタッキング可能 (3脚まで)
スツール
丸イス


丸イス 価格(税抜) サイズ(mm)梱包才数梱包重量
丸イス 4,600円 W320×H420 3.6才16kg
仕様/張地:合成皮革 脚:スチ-ル (φ19.1mm) メラミン焼付塗装 入数:10 ●スタッキング可能 (5脚まで)









HM-320 RMS-345


座裏にはスタッキング時に座面を傷つ けないよう再生PP製カバーが付いて います。
木座スツール 価格(税抜) サイズ(mm)梱包才数梱包重量
HM-320 11,000円 W320×D320×H4502.9才14kg
仕様/座板:(t21mm) 塗装 (ナチュラル) 座裏カバ-:再生PP (グレ-) フレ-ム:スチ-ル (φ19.1mm) 粉体塗装 (メタリックシルバ-) 入数:6 ●スタッキング可能 (6脚まで) ●座裏にはスタッキング時に座面 が傷つかないようPP再生樹脂が付いています。



シルバー脚

ブラック脚

リング付丸スツール 価格(税抜)サイズ(mm)梱包才数梱包重量 RMS-345B 16,000円 φ435×H4704.3才15kg RMS-345S 16,000円 φ435×H4704.3才15kg 仕様/座:t45mm 合成皮革 (PVC) 座受樹脂:ナイロン フレ-ム:スチ-ル (φ22.2mm) 粉体塗装 (シルバー /ブラック) 補強リング:スチ-ル (φ13.0mm) 粉体塗装 (シルバ-) 入数:4(1個口) ●スタッキング可能 (4 脚まで)
丸イス(ブラック) 丸イス(ライトグリーン) 丸イス(ライトブルー) 丸イス(レッド) HM-320(NA) RMS-345S(BL) RMS-345B(IV)
SC-20-NV-NV SC-20-WH-WH SC-20-RD-RD SC-20-OR-OR SC-20-GN-WH レッド ライトグリーン ライトブルー ブラック ■カラーサンプル BK:ブラック BL:ブルー IV:アイボリー ■カラーサンプル RD/RD WH/WH NV/NV ■カラーサンプル OR/OR GN/WH 背 座 392
ラウンジスツール


ラウンジスツール 価格(税抜)サイズ(mm)梱包才数梱包重量
RST-380 33,000円 φ380×H3802.4才 5kg 仕様/張地:合成皮革 (PVC) 入数:1





折畳みベンチ 価格(税抜)サイズ(mm)梱包才数梱包重量
ROB-1800 66,000円 W1800×D460×H3903.6才15.5kg
ROB-1500 65,000円 W1500×D460×H3903.0才13.5kg
仕様/座:木枠 合成皮革 (PVC) フレ-ム:スチ-ル メラミン焼付塗装 入数:1(1個口) ●バネ脚 ●折畳時:H105mm
折畳みベンチ 診察台







診察台 価格(税抜)サイズ(mm)梱包才数梱包重量
SSD-1860 99,000円 W1800×D600×H600
▲ 9.0才 ▲ 30kg
仕様/座:木枠 合成皮革 (PVC) 脚:スチ-ル (φ76.3mm) メラミン焼付塗装 入数:1

診察台 (サイドレール付) 価格(税抜)サイズ(mm)梱包才数梱包重量
SSD-1860ST 150,000円 W1800×D600×H890
仕様/座:木枠 合成皮革 (PVC) 脚:スチ-ル
▲ 9.0才 ▲ 31kg
メラミン焼付塗装 柵:スチ-ル メラミン焼付塗 装 入数:1
(φ76.3mm)
RST-380(BK)
RST-380(WH)
ROB-1800(BK)
ROB-1500(BR) スタッキング例
SSD-1860(BR)
SSD-1860ST(BK)
BK:ブラック BR:ブラウン ■カラーサンプル
WH:ホワイト BK:ブラック ■カラーサンプル
393 SOCIA
BR:ブラウン BK:ブラック IV:アイボリー ■カラーサンプル
チェアデスク・収納パーティションテーブルレセプションロビーエクステリアアクセサリー木工
幼保レンタル・リース
折畳カラーベンチ(バネ脚式・背なし)

折畳みカラーベンチ 価格(税抜) サイズ(mm)梱包才数梱包重量
FB-3S 53,000円 W1805×D415×H4002.3才17.3kg
仕様/座:樹脂成型品 (ブル-) 脚:スチ-ル (〼26mm) 粉体塗装 入数:1 ●折畳時:W1805×D415×H70
折畳みカラーベンチ 価格(税抜) サイズ(mm)梱包才数梱包重量
FB-4S 48,000円 W1505×D415×H4002.1才13.5kg
仕様/座:樹脂成型品 (ブル-) 脚:スチ-ル (〼26mm) 粉体塗装 入数:1 ●折畳時:W1505×D415×H70
カラーベンチ用部品

カラ-ベンチ用座・背板 価格(税抜)サイズ(mm)
BENTIITA18BL オープン W1795×D195
BENTIITA15BL オープン W1495×D195
仕様/本体:樹脂成型品 入数:1
アルミ折畳ベンチ


衝撃などによる脚の折畳みが起こりにくいバネ脚。


カラーベンチ用キャップ(右) カラーベンチ用キャップ(左)
カラ-ベンチ用キャップ (右) 価格(税抜)
BENTIKR オープン
仕様/本体:樹脂成型品 入数:1

バネ脚折畳みアルミ ベンチ (背なし) 価格(税抜) サイズ(mm)梱包才数梱包重量
AFB-1S 88,000円 W1800×D410×H4203.2才12kg
仕様/本体:アルミ アルマイト仕上げ 入数:1 ●折畳時:W1800×D410×H95
木製ベンチ

カラ-ベンチ用キャップ (左) 価格(税抜)
BENTIKL オープン
仕様/本体:樹脂成型品 入数:1

木製ベンチ
415 345 365 1805/1505 1540/1240 400 70 折り畳み時 折り畳み時 410 420 1800 1495 365 95
価格(税抜) サイズ(mm)梱包才数梱包重量 MB-1530 42,000円 W1500×D300×H4002.6才10kg 仕様/座板:合板 (t21mm) ソフトエッジ (ブラック) フレ-ム:スチ-ル 粉体塗装 入数:1 木製ベンチ 価格(税抜) サイズ(mm)梱包才数梱包重量 MB-1830 43,000円 W1800×D300×H4003.2才13kg 仕様/座板:合板 (t21mm) ソフトエッジ (ブラック) フレ-ム:スチ-ル 粉体塗装 入数:1
FB-4S(BL)
FB-3S(BL)
BENTIITA18BL
AFB-1S
AFB-1S
MB-1830
バネ機構により開閉時に脚がしっかりと固定されます。 使用中や持ち運びの際に不用意に脚が開閉しない安全設計です。 394
MB-1530
三ツ折衝立

楢-88(ホワイト)

折り畳み例
三ッ折衝立 価格(税抜)サイズ(mm)梱包才数梱包重量
楢-88(ホワイト) 168,000円 W1800×D400×H2000 ▲ 6.0才28.5kg
楢-88(アイボリー) 146,000円 W1800×D400×H2000 ▲ 6.0才28.5kg
仕様/パネル部:ポリエステル化粧板 パネル枠:アルミ押出成型品 アルマイト仕上げ 脚:アルミダイカスト 入数:1 ●折畳時:W620×D400×H2000 ●別注にてストッパ-付に変更可能。
楢 三ツ折衝立用補強脚

STP-HO
楢補強脚 価格(税抜)サイズ(mm)梱包才数梱包重量
STP-HO 28,000円 W630×D440×H1451.8才4kg
仕様/本体:スチ-ル 粉体塗装 入数:1
アクリルパネル SMP-AR


マグネットパーティション 価格(税抜)サイズ(mm)梱包才数梱包重量
SMP-1809AR 45,900円 W900×D20×H1825 ▲ 2.6才13.4kg
SMP-1509AR 39,800円 W900×D20×H15252.2才11.4kg
仕様/枠:スチ-ル 粉体塗装 (シルバ-) パネル:AR/アクリル樹脂 (t3.0mm) 入数:1



楢-66(アイボリー)
三ッ折衝立 価格(税抜)サイズ(mm)梱包才数梱包重量 楢-66(ホワイト) 151,000円 W1800×D400×H17205.3才25kg
楢-66(アイボリー) 135,000円 W1800×D400×H17205.3才25kg
仕様/パネル部:ポリエステル化粧板 パネル枠:アルミ押出成型品 アルマイト仕上げ 脚:アルミダイカスト 入数:1 ●折畳時:W620×D400×H1720 ●別注にてストッパ-付に変更可能。



SMP安定脚 (キャスター脚) 価格(税抜)梱包才数梱包重量
SMP-FK 4,000円 0.1才1.1kg
仕様/本体:スチ-ル 粉体塗装 (シルバ-) キャスタ-:樹脂成型品 入数:1 ●キャスタ-仕様の場合、パネル高が42mm高くなります。 ※キャスタ-脚仕様でのご使用の場合、 連結金具は使用できません。SMP-FKに関しましては単体パルでのご使用に限りお使いください。
SMP安定脚 (アジャスター脚) 価格(税抜)梱包才数梱包重量
SMP-F 3,800円 0.1才1kg
仕様/本体:スチ-ル 粉体塗装 (シルバ-) アジャスタ-:樹脂成型品 入数:1
●アジャスタ-仕様の場合、パネル高は変わりません。
取付時
SMP-1809AR+SMP-FK×2
SMP-1809AR+SMP-F×2
ホワイト アイボリー ■カラーサンプル 395 SOCIA
SMP-FK SMP安定脚(キャスター脚) SMP-F SMP安定脚(アジャスター脚)
チェアデスク・収納パーティションテーブルレセプションロビーエクステリアアクセサリー木工 幼保レンタル・リース
折畳式ステージ台

STG-400B
耐荷重:全体平均分布で120Kg

STG-400G

スタッキング例
STG-600
折畳式ステージ台 (ブラック脚) 折畳式ステージ台 (ゴールド脚) 価格(税抜)サイズ(mm)梱包才数梱包重量

(t15mm) フレ-ム:スチ-ル (〼31mm) メラミン焼付塗装 入数:1
注意事項 STG-200は折り畳みが出来ない仕様になっています。
アルミポータブルステージ

バネ脚 スプリングの張力を利用することで、衝撃などに よる脚の折り畳み事故を防止する脚を採用してい ます。

STG-400
STG-200
※こちらの商品は大型商品のため、別途で運賃が必要になります。


アルミポータブルステージ 価格(税抜) サイズ(mm)梱包才数梱包重量
ATPS-246AL 1,069,000円 W2400×D1200×H200~600 ▲ 37.5才 ▲ 86kg 仕様/天板:ナラ市松貼積層合板 (t24mm) UV塗装 フレ-ム・脚:アルミ アルマイト加工 入数:1(1個口) ●転倒防止ストッパ-付 ●φ100㎜ キャスタ- (ストッパ-付)
アルミステップ

ANSS-400AL
ANSS-200AL
ATPS-246AL

アルミステップ 価格(税抜)サイズ(mm)梱包才数梱包重量
ANSS-400AL 162,000円 W985×D625×H49013.1才14.5kg
ANSS-200AL 103,000円 W985×D320×H2904.5才7kg
ANSS-100AL 102,000円 W985×D320×H2403.1才6.5kg
仕様/天板:ナラ単板市松貼 (t24mm) UV塗装 フレ-ム:アルミ (φ25.4×t2.0mm) 入数:1 ●脚ゴム付
スカート





ANSS-100AL
ANSS-100AL
ANSS-200AL



ステージ用スカート (1m当り)

ANSS-400AL


価格(税抜)サイズ(mm) 梱包重量
ANSC-6 40,000円 H6003.5kg
ANSC-4 27,000円 H4002.5kg
ANSC-2 20,000円 H2001.5kg 仕様/スカ-ト:別珍 (2倍ヒダ)
900 985 296 318 240 100 73 140 900 985 296 318 290 200 173 90 900 985 296 623 200 490 173 90 296 200 2400 1200 548 1290 19 8・ 39 8・ 598 折り畳み時 842 842 1800 822 900 200 154 842 842 1800 822 900 400 354 82 139 折り畳み時 842 842 1800 706 900 600 554 82 339 折り畳み時 822
STG-600BSTG-600G 131,000円 W1800×D900×H600 ▲ 5.3才 ▲ 38kg STG-400BSTG-400G 131,000円 W1800×D900×H400 ▲ 5.3才 ▲ 36kg STG-200BSTG-200G 127,000円 W1800×D900×H200 ▲ 12.4才 ▲ 31kg 仕様/天板:合板
入数:1 ●マジックテ-プ加工
H600時 H400時 H200時
折畳時
MGN:モスグリーン GL:ゴールド DRD:エンジ BR:ブラウン WN:ワインレッド BK:ブラック NV:ネイビー ■カラーサンプル 396
ANSC-2(DRD)
ANSC-2(MGN) ANSC-2(GL)
折畳演説台


折畳み演説台 価格(税抜)サイズ(mm)梱包才数梱包重量
EDA-1200 367,000円 W1200×D450×H9505.3才 25kg
仕様/本体:ポリ化粧板 フラッシュ加工 (t26.5mm) 天板・棚板:メラミン化粧板 (t26.5mm) 入数:1(1個口)
司会者台


司会者台 価格(税抜)サイズ(mm)梱包才数梱包重量
SKD-6045(RO/TE) 256,000円 W600×D450×H110012.0才 20kg
SKD-6045(WH) 230,000円 W600×D450×H110012.0才 20kg
仕様/天板・棚板:メラミン化粧板 側板・幕板:ポリ化粧板 エッジ:メラミン化粧板 巾木:メラミン化粧板 入数:1
屏風







■カラーサンプル





屏風 価格(税抜)サイズ(mm)梱包才数梱包重量
FSL-68 567,000円 W3600×H2410 ▲ 9.8才20kg
FSL-67 399,000円 W3300×H2110 ▲ 7.9才18kg
FSL-66 357,000円 W3000×H1818 ▲ 6.3才15kg
仕様/表面:特殊印刷金紙 裏面:紺色布 芯:特殊ボ-ド 入数:1
抗ウイルス屏風 ケース



抗ウイルス屏風 価格(税抜)サイズ(mm)梱包才数梱包重量
VSL-68 567,000円 W3600×H2410
VSL-67 399,000円 W3300×H2110
VSL-66 357,000円 W3000×H1818
▲ 9.8才20kg
▲ 7.9才18kg

幼保レンタル・リース
屏風ケース 価格(税抜)サイズ(mm)梱包才数梱包重量
FBK-8 168,000円 W150×D795×H2455 ▲ 13.7才11kg
FBK-7 82,000円 W150×D760×H2150 ▲ 11.1才8kg
FBK-6 75,000円 W150×D680×H1850 ▲ 8.9才6kg
仕様/本体:プラスチック段ボ-ル 入数:1
1200 1200 1145 950 450 418330 412 150 93 折り畳み時 422 450 1100 1000 548 600 49845099 275
▲ 6.3才15kg 仕様/表面:抗ウイルスビニ-ル壁紙 裏面:紺色布 (抗菌スプレ-塗布) 芯:特殊ボ-ド 入数:1
配線ホール
折畳時 FBK-6 RO:ローズ TE:チーク WH:ホワイト WH:ホワイト
EDA-1200(RO) EDA-1200
FSL-66(GL) FSL-66(SV) VSL-68(IV)
TE:チーク
■カラーサンプル RO:ローズ
GL:ゴールド
■カラーサンプル 天板、棚板取り外し可能
SV:シルバー
■カラーサンプル IV:アイボリー
内側 内側 397 SOCIA
SKD-6045(TE)
チェアデスク・収納パーティションテーブルレセプションロビーエクステリアアクセサリー木工
宴会テーブル

※天然木を使用しているため天板の色が異なる可能性があります。

宴会テーブル (円型) 棚 天板仕様 価格(税抜)サイズ(mm) 梱包才数梱包重量
ET-2000R
ET-1800R
ET-1500R
ET-1200R
ET-900R
棚無し ソフトエッジ
243,000円 φ2000×H700 ▲ 16.6才 ▲ 35kg
163,000円 φ1800×H700 ▲ 13.4才28kg
152,000円 φ1500×H700 ▲ 9.4才24kg
86,000円 φ1200×H700 6.0才23kg
67,000円 φ900×H700 3.4才14kg
仕様/天板:シナベニヤ (t28mm) ソフトエッジ フレ-ム:スチ-ル (〼26mm) メラミン焼付塗装 入数:1 ●バネ脚 ●折畳時:2000R、1800R、1500R、1200RはH900mm、900RはH120mm


宴会テーブル (半円型) 棚 天板仕様 価格(税抜)サイズ(mm) 梱包才数梱包重量
ET-1500RH
ET-1800RH 棚無し ソフトエッジ
ET-1200RH
ET-900RH
97,000円 W1800×D900×H7006.1才18kg
91,000円 W1500×D750×H7005.2才17kg
61,000円 W1200×D600×H7002.8才14kg
58,000円 W900×D450×H7002.1才12kg 仕様/天板:シナベニヤ (t28mm) ソフトエッジ フレ-ム:スチ-ル (〼26mm) メラミン焼付塗装 入数:1 ●バネ脚 ●折畳時:1800RH、1500RH、1200RHはH900mm、900RHはH120mm


フライト式宴会 テーブル 棚 天板仕様 価格(税抜)サイズ(mm) 梱包才数梱包重量
ETZ-1800
250,000円 φ1800×H700 31.0才 ▲ 51kg
ETZ-1500 236,000円 φ1500×H700 25.9才 ▲ 43kg
棚無し ソフトエッジ
ETZ-1200 177,000円 φ1200×H700 20.8才 ▲ 32kg
ETZ-900 157,000円 φ900×H700 15.7才 ▲ 31kg
仕様/天板:シナベニヤ (t28mm) ソフトエッジ フレ-ム:スチ-ル (φ31.8mm) メラミン焼付 塗装 (トウホウ色) 入数:1 ●指挟み防止機構付 ●単輪ウレタンキャスタ-仕様
※天板を真中から折り畳む形状をしたテーブルをフライト式テーブル、フライトテーブルと称しています。


ターンテーブル 天板仕様価格(税抜)サイズ(mm)梱包才数梱包重量 TT-900 ソフトエッジ 76,000円 φ900×H552.7才13kg
仕様/天板:メラミン化粧板 (t21mm) ソフトエッジ 回転板:スチ-ル 入数:1


宴会テーブル (長方形) 棚 天板仕様 価格(税抜)サイズ(mm) 梱包才数梱包重量
ET-1890
ET-1875
ET-1860
ET-1845
ET-0909
棚無し ソフトエッジ
91,000円 W1800×D900×H700 ▲ 6.1才21kg
88,000円 W1800×D750×H7005.2才17kg
61,000円 W1800×D600×H7004.2才15kg
51,000円 W1800×D450×H7003.2才15kg
62,000円 W900×D900×H7003.4才14kg
仕様/天板:シナベニヤ (t28mm) ソフトエッジ フレ-ム:スチ-ル (〼26mm) メラミン焼付塗装 入数:1 ●バネ脚 ●折畳時:H90mm


フライト式宴会 テーブル 棚 天板仕様 価格(税抜)サイズ(mm) 梱包才数梱包重量
ETZ-K1890
ETZ-K1875 161,000円 W1800×D750 ×H700 18.4才 ▲ 36kg
棚無し ソフトエッジ 172,000円 W1800×D900 ×H700 22.0才 ▲ 39kg
ETZ-K1860 135,000円 W1800×D600 ×H700 14.8才 ▲ 32kg
ETZ-K1845 122,000円 W1800×D450 ×H700 11.2才 ▲ 31kg
仕様/天板:シナベニヤ (t28mm) ソフトエッジ フレ-ム:スチ-ル (φ31.8mm) メラミン焼付 塗装 (トウホウ色) 入数:1 ●指挟み防止機構付 ●ナイロンキャスタ-仕様

指挟み防止機構付 天板が平らになる直前に天板が ロックされる指挟み防止機構付。 両手で手前のレバーを矢印の方向 に回してロックを解除し、天板を平 らにします。
ET-900R
ET-1200R
TT-900
天板裏面
ET-1800RH
ET-1500RH
ET-1890
ET-0909
ETZ-1200
ETZ-K1860 折り畳み時 折り畳み時
注意
398
食器棚
チェアデスク・収納パーティションテーブルレセプションロビーエクステリアアクセサリー木工


SDP-1800(WH)(使用例)
食器棚 価格(税抜)サイズ(mm)梱包才数梱包重量
SDP-1800 49,000円 W600×D395×H1800 ▲ 4.4才 ▲ 33.6kg

棚板調節 棚板は30mmピッチで調 整が可能です。

マグネットラッチ機構 扉の表面を軽く押すだけでスムーズに開閉が可 能。扉の内側にマグネットがついており、磁力で 扉を固定します。

転倒防止補助バンド 付属の樹脂バンドで食器棚と壁 面を固定でき、転倒防止対策。
■カラーサンプル


ホワイトボード

仕様/パ-ティクルボ-ド プリント紙化粧板貼り 入数:1 ●可動棚5枚付

コートハンガー







粉受
マーカーとイレイザーが付属します。 ワンタッチストッパーを押すと、 板面が回転でき、また確実に固 定します。
ダブルロック機構 1度のロックで、車輪と車輪の軸をロックすることで、ボー ドの動きをおさえ安定した状態で使用できます。
スチール両面 ホワイトボード 価格(税抜) サイズ(mm)梱包才数梱包重量
WBS-1209RF 52,000円 W1290×D525×H18103.6才16.4kg
仕様/●ボ-ド:スチ-ル フレ-ム:スチ-ル 粉体塗装 (ホワイト) 入数:1(2個口) ●ボ-ド:W1210×D19×H910 ●回転ストッパ-付 ●キャスタ-:ダブルロック機構付4個 ●粉受付 ●マ-カ- (赤・黒)・イレイザ-付
スチール両面 ホワイトボード 価格(税抜) サイズ(mm)梱包才数梱包重量
WBS-1809RF 66,000円 W1890×D525×H1810 ▲ 5.2才21.2kg 仕様/ボ-ド:スチ-ル フレ-ム:スチ-ル 粉体塗装 (ホワイト) 入数:1(2個口) ●ボ-ド:W1810×D19×H910 ●回転ストッパ-付 ●キャスタ-:ダブルロック機構付4個 ●粉受付 ●マ-カ- (赤・黒)・イレイザ-付

コートハンガー 価格(税抜)サイズ(mm) 梱包才数梱包重量
HK-1600 47,600円 W1600×D515×H16002.3才11kg
HK-1200 45,400円 W1200×D515×H16002.3才10kg
HK-900 44,300円 W900×D515×H16002.3才9kg
HK-600 42,200円 W600×D515×H16002.3才8kg
仕様/本体:スチ-ル 楕円パイプ (46×20mm) メラミン焼付塗装 (グレ-) ハンガ-パ イプ:スチ-ル (φ25.4mm) クロ-ムメッキ φ40mm双輪キャスタ-付 入数:1 ●耐荷重80kg


幼保レンタル・リース
ACHHANGA
オプションハンガー (黒・5本セット)
コートハンガー 価格(税抜)サイズ(mm) 梱包才数梱包重量
HK-1600B 47,600円 W1600×D515×H16002.3才11kg
HK-1200B 45,400円 W1200×D515×H16002.3才10kg
HK-900B 44,300円 W900×D515×H16002.3才9kg
HK-600B 42,200円 W600×D515×H16002.3才8kg
仕様/本体:スチ-ル 楕円パイプ (40×20mm) 粉体塗装 (マットブラック) ハンガ-パ イプ:スチ-ル (φ25.4mm) クロ-ムメッキ φ40mm双輪キャスタ-付 入数:1 ●耐荷重80kg
4,000円(税抜) サイズ:W420×D35×H230mm 入 数:1 梱包才数:0.7才 梱包重量:0.6kg 仕様/樹脂成型品
SDP-1800(NA)
WBS-1809RF
HK-600
HK-900
HK-1200B
HK-1600B
ACHHANGA
NA:ナチュラル WH:ホワイト
399 SOCIA
チェーンパーティション(ゴム付ベース)

OCP-1G(WH)

チェーンパーティション 価格(税抜)サイズ(mm)梱包才数梱包重量
OCP-1G 29,600円 φ353×H8220.7才5kg
仕様/支柱:スチ-ル (φ31.8mm) メラミン焼付塗装 ベ-ス:スチ-ル (t4.5mm) ゴム巻:クロロプレンゴム (t8mm) 入数:1
アルミベルトパーティション



ゴムエッジ仕様 床面に傷をつけないよ うエッジをゴム巻にして あります。

スタッキング例






アルミベルトパーティション 価格(税抜)サイズ(mm)梱包才数梱包重量
ABP-BK 52,000円 W350×D350×H9000.4才5.3kg
ABP-SV 52,000円 W350×D350×H9000.4才5.3kg
仕様/支柱:アルミ押出材 粉体塗装 (シルバー/ブラック) ベ-ス:スチ-ル (t4.5mm) 粉体塗装 (シルバー/ブラック) ベルト:ナイロン ヘッド部:ABS樹脂 入数:1(2個口) ●スタッキング可能 ●ベルト有効長さ 2m



 ABP-BK
ABP-BK
製品 支柱 ベース取付け部 ベース スタッキング時 ネオジウム磁石 取外し可能な為、 ヘッド部のみで使用も可能です。 各部パーツ ズレ防止部 ※支柱同士を積み重ねて運ぶ際のズレ防止箇 所(反対面にもあり) ストッパー ストッパー挟み込み部 ズレ防止部
BL:ブルー
400
ABP-SV
ヘッド取外し状態
RD:レッド
BK:ブラック ■ベルトカラーサンプル








インスタントポール
天井高 最大5m対応


冠婚葬祭・イベントなどの 紅白幕の設営に。 イベント会場のボード取り付けに。 飛沫感染対策用の ビニールシート等の取り付けに。
詳しくはこちら
商品解説動画が ご覧いただけます。
吊看板・紅白幕などの設営に便利なインスタントポール。 釘を使わず、ワンタッチで設営可能です。アルミ製なので、軽量・丈夫! 長さ違いで2種類ご用意!
インスタントポール 価格(税抜)サイズ(mm)梱包才数梱包重量
ISP-1950 33,000円 φ60×H1920~50053.0才13.5kg
ISP-1833 25,000円 φ60×H1860~33903.0才10.5kg
仕様/パイプ:アルミ ゴム 金具:スチ-ル 入数:6
●ISP-1950:3段階延長可能・ISP-1833:2段階延長可能
伸縮します

レバーを解除


幼保レンタル・リース
下部の金具を踏み込む事で簡単 に突っ張ることができます。 耐荷重:1本10kg




十手金具

吊金具
ISP-1833
ISP-1950
第24回
定時株主総会 受付
401 SOCIA
チェアデスク・収納パーティションテーブルレセプションロビーエクステリアアクセサリー木工
ECOLOGY
■ 環境対応商品マークについて
グリーン購入法適合商品マーク
グリーン購入法適合商品について
本カタログでは、より地球に優しい、より環境に配慮した製品をお客様に選んでいただけるよう商品設計 からカタログ制作まで積極的に取り組んでいます。グリーン購入法の施工に伴い、「グリーン購入法適合 商品」が分かりやすく検索できるように工夫しています。これからも、お客様に安心して商品をご購入い ただけるよう、より詳しい商品の環境対応情報を提供してまいります。
■ 特定調達品目及びその判断基準(抜粋) ※本誌に掲載されている商品に適合する品目及びその判断基準のみを抜粋しています。
品目
機器類 いす
机 棚
収納用什器(棚以外)
ローパーテーション
コートハンガー
傘立て
掲示板
黒板
ホワイトボード
【判断基準】以下、A、B、C、Dのいずれかの要件を満たすこと。
判断基準及び配慮事項
A.大部分の材料が金属類である棚又は収納用什器にあっては以下の要件を満たすこと。
・表1に示された区分の製品にあっては、以下のア、イ及びウの要件を満たすこと。
・それ以外の場合にあっては、イ及びウの要件を満たすこと。
表1
※棚板に適用される機能重量の基準の算出方法 機能重量の基準=棚板重量(kg)÷棚耐荷重(kg)
ア、区分ごとの基準を上回らないこと
イ、単一素材分解可能率が90%以上であること。
ウ、表2の評価項目ごとに評価基準に示された環境配慮設計がなされていること 表2
目的 評価項目 評価基準 リデュース配慮設計 原材料の使用削減原材料の使用量の削減をしていること 軽量化・減量化部品・部材の軽量化・減量化をしていること
リサイクル配慮設計 再生可能材料の使用再生可能な材料を使用していること 再生可能材料部品の 分離・分解の容易化 再生可能な材料を使用している部分は部品ごとに簡易に分離・分解できる接合方法であること。 その他の部品は容易に取り外しができること
再生資源としての利用 合成樹脂部分の材料表示を図っていること 材質ごとに分別できる工夫を図っていること
それ以外の場合にあっては金属を除く主要材料が下記のいずれかの要件を満たすこと。
B.プラスチックの場合にあっては、再生プラスチックがプラスチック重量10%以上使用されていること。
C.木質の場合にあっては間伐材などの木材が使用されていること。また材料からホルムアルデヒドの放散速度が0.02mg/㎡h以下又はこれと同等のもので あること。
※放散速度が0.02mg/㎡h以下と同等のものとは、次によるものとする。
ア、対応した日本工業規格又は日本農林規格があり、当該規格にホルムアルデヒドの放散量の基準が規定されている木質材料についてはF☆☆☆の基準を 満たしたもの
イ、上記ア以外の木質材料については、JIS A1460の規定する方法等により測定した数値が次の数値以下であるもの。
D.紙の場合にあっては、紙の原料は古紙配合率50%以上であること。
E.保守部品又は消耗品の供給期間は、当該商品の製造終了後5年以上とすること。 区分 基準 収納庫(カルテ収納棚等の特殊用途は除く。)の棚板0.1 棚(書架・軽量棚・中量棚)の棚板 0.1
MAINTENANCE
木製品の点検及び保守管理について
この度は当社製品をお買い求めいただきましてありがとうございます。末永くお使いいただくため、 定期的な点検及び保守管理をお願いいたします。点検及び保守管理には、市販の木材保護塗料等をお使いください。 (その際は、ご使用になる塗料等の注意事項をよくお読みの上、お使いくださいますようお願いいたします。)
■ 塗布上の注意事項
●作業する際は保護手袋、保護マスク等を使用してください。
●塗布の際は、換気が行える場所で行ってください。塗料の臭いが充満し、気分が悪くなることがあります。
●製品が十分乾燥していることをご確認の上、塗布してください。
●塗布の際は表面の旧塗膜を完全に除去し、ゴミ、ほこり等を除去してください。
●摩擦の激しい面は色落ちが早くなることがありますので、こまめに重ね塗りを行ってください。
また、色落ちにより、衣服を汚す恐れがありますので乾燥後にウエス等で乾拭きしてください。
●木材保護塗料塗布後の点検及び保守管理について。
気候、設置場所等によって塗り替え時期は異なってきますが、次の状態になった時を目安に塗り替えを行ってください。
1.汚れが著しくなったとき 2.退色が激しくなったとき 3.撥水性が低下したとき
■ 塗装方法
1.製品をよく乾燥させ、表面の塗膜をサンドペーパー等により取り除いてください。
2.ハケにむらのないように少なくとも2回塗りをしてください。とくに強い耐候性を必要とする場合は3回塗布してください。 ※塗り重ねの際は十分に乾燥させ、塗り重ねてください。
3.色落ちにより衣服等を汚す恐れがありますので、乾燥後ウエス等で乾拭きしてください。
※使用後のハケ等の後始末は、乾かないうちにうすめ液等でよく洗ってください。 また、乾拭きに使用したウエスは塗料等の種類によっては自然発火する危険がありますので塗料等の注意事項をよくお読みの上、 適切な処分をお願いいたします。
402 388
平均値 最大値 0.5mg/L 0.7mg/L
CFL-T80………………………………235
CFL-T80B………………………………235
CK01……………………………………79
CK01-AR………………………………79
CK01-HR………………………………79
CK02……………………………………80
CK02-AR…………………………… 80・81
CK03……………………………………81
CKH11……………………………… 54・77
CKH11-AR………………………… 54・77
CKH22…………………………………75
CKH22-AR……………………………75
CKH22-HR……………………………75
CMC-110………………………………297
Combi。……………………………69・310
Combi。+G-OVT16…………………69
Combi。+G-TN18……………………69
CRT-36S………………………………125
CW-1……………………………………268
CW-11…………………………………269
CW-11A………………………………269
CW-12…………………………………269
CW-1A…………………………………268
CW-2……………………………………268
DDB-1……………………………………302
DB-2……………………………………302
DC-430P………………………130・346
DC-530P………………………129・346
DC-730P………………………130・346 E
EA-CH…………………………………121
EBD-02…………………………………308
EBD-B2…………………………………304
EBD-B2-OS……………………………304
EBD-B2+EBD-B2-OC………………304
EBD-B2+EBD-B2-OC+EBD-B2-OCOP… ………………304
EDA-1200……………………………397
EL-4□-HS-□□………………………103
EL-4□-ZR-□□………………………103
EL-4B-□□-□□………………………105
EL-4B-HS-□□…………………………104
EL-4B-ZR-□□…………………………104
EL-4W-□□-□□………………………105
EL-4W-HS-□□………………………104
EL-4W-ZR-□□………………………104
EL-6□-HS-□□………………………100
EL-6□-ZR-□□………………………100
EL-6B-□□-□□………………………102
EL-6B-HS-□□…………………………101
EL-6B-ZR-□□…………………………101
EL-6W-□□-□□………………………102
EL-6W-HS-□□………………………101
EL-6W-ZR-□□………………………101
EL-8……………………………………98
EL-CV……………………………100・103
EL-SN……………………………………100
EL-ST……………………………………103
ENB-1200……………………………369
ENC-250………………………………371
ENR-K…………………………263・365
ENR-O…………………………263・364
ENR-S……………………………263・364
ENT-1260V……………………………370
ENT-9060V……………………………370
ENT-D330V……………………………370
ENT-K330V……………………………370
ET-0909………………………232・398
ET-1200R ……………………232・398
ET-1200RH ……………………232・398
ET-1500R………………………232・398
ET-1500RH… …………………232・398
ET-1800R………………………232・398
ET-1800RH……………………232・398
ET-1845………………………232・398
ET-1860………………………232・398
ET-1875………………………232・398
ET-1890 ………………………232・398
ET-2000R………………………232・398
ET-900R… ……………………232・398
ET-900RH………………………232・398
ETZ-1200………………………233・398
ETZ-1500………………………233・398
ETZ-1800………………………233・398
ETZ-900………………………233・398
ETZ-K1845……………………233・398
ETZ-K1860……………………233・398
ETZ-K1875……………………233・398
ETZ-K1890……………………233・398
FFAP-210………………………………273
FB-1B……………………………………270
FB-2B……………………………………270
FB-3……………………………………147
FB-3S……………………………270・394
FB-4S……………………………270・394
FBK-6……………………………………397
FBK-7……………………………………397
FBK-8……………………………………397
FC-1260………………………………371
FC-570P………………………130・348
FC-670P………………………………347
FCK-1260………………………………371
FDC-1212B……………………………205
FDC-1212W…………………………205
FDC-2412B……………………………204
FDC-2412W…………………………204
FDC-3612B……………………………205
FDC-3612W…………………………205
FP-930…………………………125・390
FPS-100………………………………279
FPS-90…………………………………279
FSL-66…………………………………397
FSL-67…………………………………397
FSL-68…………………………………397
FW-635………………………………292
FW-906………………………………292
FW-935………………………………292
FW-A635………………………………292
FW-M935……………………………292
FW-W635……………………………292
G
G-2TH…………………………………71
G-AG……………………………………73
G-AGL…………………………………73
G-AP15…………………………………70
G-B………………………………………71
G-FR……………………………………71
G-GH……………………………………71
G-GL……………………………………71
G-HIB…………………………68・299・322
G-IB…………………………68・299・322
G-KB135………………………………70
G-KSP……………………………………71
G-MLGW……………………68・299・322
G-MLL………………………68・299・322
G-MS18………………………………70
G-MSG…………………………………71
G-OVT16………………………………70
G-PK90…………………………………71
G-PLP……………………………………71
G-SMG………………………68・299・322
G-STL16………………………………70
G-TH……………………………………71
G-TN18…………………………………70
G-TP1…………………………………73
G-TP2…………………………………73
G-WBDX………………………………72
G-WBL…………………………………72
G-YK16…………………………………70
GD-O7045……………………………319
GD-P8060……………………………318
GD-S1200……………………………319
GTA-1245BSE………………………375
GTA-1245SSE…………………………375
GTA-1260BSE………………………375
GTA-1260SSE…………………………375
GTA-1845BSE………………………375
GTA-1845SSE…………………………375
GTA-1860BSE………………………375
GTA-1860SSE…………………………375
GTA-9045BSE………………………375
GTA-9045SSE…………………………375
GTA-9060BSE………………………375
GTA-9060SSE…………………………375
GTA-A1245BSE………………………375
GTA-A1245SSE………………………375
GTA-A1260BSE………………………375
GTA-A1260SSE………………………375
GTA-A1845BSE………………………375
GTA-A1845SSE………………………375
GTA-A1860BSE………………………375
GTA-A1860SSE………………………375
GTS-1245BSE…………………………374
GTS-1245SSE…………………………374
GTS-1260BSE…………………………374
GTS-1260SSE…………………………374
GTS-1845BSE…………………………374
GTS-1845SSE…………………………374
GTS-1860BSE…………………………374
GTS-1860SSE…………………………374
GTS-9045BSE…………………………374
GTS-9045SSE…………………………374
GTS-9060BSE…………………………374
GTS-9060SSE…………………………374
GTS-A1245BSE………………………374
GTS-A1245SSE………………………374
GTS-A1260BSE………………………374
GTS-A1260SSE………………………374
GTS-A1845BSE………………………374
GTS-A1845SSE………………………374
GTS-A1860BSE………………………374
GTS-A1860SSE………………………374
HHCT-1245……………………………294
HCT-945………………………………294
HCT-C445……………………………294
HD-790…………………………204・207
HK-1200………………………298・399
HK-1200B………………………298・399
HK-1600………………………298・399
HK-1600B………………………298・399
HK-600…………………………298・399
HK-600B………………………298・399
HK-900…………………………298・399
HK-900B………………………298・399
HM-320………………………133・392
HP-330BK………………………………94
HP-330LG………………………………94
HP-330MS……………………………94
HTC-4545WK…………………………229
HTC-6045WK…………………………229
HTC-7545WK…………………………229
I
ISP-1833………………………………401
ISP-1950………………………………401
J
JA-1……………………………………266
JA-1A……………………………………266
JA-1AN…………………………………267
JA-1N…………………………………267
JEE-5638T……………………………385 JEE-6138M……………………………385
JEE-6138T……………………………385
JEE-6638M……………………………385
JEE-6638T……………………………385
JEE-7638M……………………………385
JEE-7638T……………………………385
K
K-102S…………………………………277
K-102T…………………………………276
K-27S……………………………………277
K-27T……………………………………276
K-48S……………………………………277
K-48T……………………………………276
K-921……………………………………89
K-921PU………………………………89
K-922……………………………………90
K-926……………………………………93
K-928……………………………………91
K-92S……………………………………277
K-92T……………………………………276
K-932……………………………………93
K-F48T…………………………………278
K-F57A…………………………………278
K-F81A…………………………………278
K-F92T…………………………………278
K-SOB…………………………………369
KAN-035………………………………280
KAN-050………………………………280
KAN-065………………………………280
KAP-1000………………………………138
KAP-1200………………………………138
KAP-1400………………………………138
KAS-1……………………………………278
KAS-2……………………………………278
KAS-B……………………………………278
KAW-12………………………………147
KAW-13………………………………147
KBES-2…………………………………309
KBES-2EH………………………………309
KBM-301………………………………305
KBM-302L……………………………305
KBM-401L……………………………305
KBS-103………………………………306
KBS-201LK……………………………306
KBS-202R………………………………306
KBS-203………………………………305
KBS-203C………………………………305
KBS-203R………………………………305
KBS-212………………………………306
KBS-212CB……………………………306
KBS-212CG……………………………306
KBS-50…………………………………147
KBS-70…………………………………147
KBS-80…………………………………147
KCD-L27………………………………125
KCD-T30………………………………125
KE-WM…………………………………368
KFP-1000………………………………138
KFP-1200………………………………138
KFP-1400………………………………138
KFW-20………………………………146
KFW-30………………………………146
KFW-40………………………………146
KG-1845………………………228・383
KG-1845T……………………………228
KG-1860………………………228・383
KG-1860T……………………………228
KID-1150………………………………262
KID-900………………………………262
KID-B925………………………………262
KID-C1150……………………………262
KID-I250………………………………262
JA-2……………………………………267
JA-2N…………………………………267
JCH-470B………………………………122
JCH-470W……………………………122
KID-K10………………………………262
KID-K20………………………………262
KID-K30………………………………262
KID-M90………………………………262
GA-S33…………………………………273
JEE-5638M……………………………385
KK-120H………………………………288
404
KK-90H…………………………………288
KK-OP…………………………………288
KK-P120………………………………288
KK-P90…………………………………288
KLK-304………………………………309
KLK-308………………………………309
KLK-408-1……………………………309
KMB-700………………………………291
KMO-800………………………………291
KNC-300L……………………………297
KNM-330………………………………285
KNM-340………………………………285
KNM-350………………………………285
KOL-F1…………………………………83
KONS-C………………………………309
KONS-D………………………………309
KONS-E…………………………………309
KONS-F…………………………………309
KOSD-C………………………………309
KOSD-D………………………………309
KOSD-E…………………………………309
KOSD-F…………………………………309
KOSS-C…………………………………309
KOSS-D…………………………………309
KOSS-E…………………………………309
KOSS-F…………………………………309
KOT-1080……………………………246
KOT-580………………………………246
KP-C105………………………………283
KP-C205………………………………283
KP-C305………………………………283
KPV-15-3F……………………………181
KPV-15-3P……………………………181
KPV-15-3V……………………………181
KPV-15-4F……………………………181
KPV-15-4P……………………………181
KPV-15-4V……………………………181
KPV-18-3F……………………………181
KPV-18-3P……………………………181
KPV-18-3V……………………………181
KPV-18-4F……………………………181
KPV-18-4P……………………………181
KPV-18-4V……………………………181
KPV-21-3F……………………………181
KPV-21-3P……………………………181
KPV-21-3V……………………………181
KPV-21-4F……………………………181
KPV-21-4P……………………………181
KPV-21-4V……………………………181
KPZ-1506F……………………………171
KPZ-1506P……………………………171
KPZ-1506V……………………………171
KPZ-1509F……………………………171
KPZ-1509P……………………………171
KPZ-1509V……………………………171
KPZ-1512F……………………………171
KPZ-1512P……………………………171
KPZ-1512V……………………………171
KPZ-1806F……………………………171
KPZ-1806P……………………………171
KPZ-1806V……………………………171
KPZ-1809F……………………………171
KPZ-1809P……………………………171
KPZ-1809V……………………………171
KPZ-1812F……………………………171
KPZ-1812P……………………………171
KPZ-1812V……………………………171
KPZ-2106F……………………………171
KPZ-2106P……………………………171
KPZ-2106V……………………………171
KPZ-2109F……………………………171
KPZ-2109P……………………………171
KPZ-2109V……………………………171
KPZ-2112F……………………………171
KPZ-2112P……………………………171
KPZ-2112V……………………………171
KPZ-BR…………………………………173
KPZ-DL2109F…………………………171
KPZ-DL2109P…………………………171
KPZ-DL2109V………………………171
KPZ-DR2109F………………………171
KPZ-DR2109P………………………171
KPZ-DR2109V………………………171
KPZ-EC153J…………………………173
KPZ-EC15LJ…………………………173
KPZ-EC15SJ…………………………173
KPZ-EC183J…………………………173
KPZ-EC18LJ…………………………173
KPZ-EC18SJ…………………………173
KPZ-EC213J…………………………173
KPZ-EC21LJ…………………………173
KPZ-EC21SJ…………………………173
KPZ-H3…………………………………172
KPZ-H4…………………………………172
KPZ-HE…………………………………172
KPZ-HL…………………………………172
KPZ-HS…………………………………172
KPZ-JK153J……………………………172
KPZ-JK154J……………………………172
KPZ-JK15LJ……………………………172
KPZ-JK15SJ……………………………172
KPZ-JK183J……………………………172
KPZ-JK184J……………………………172
KPZ-JK18LJ……………………………172
KPZ-JK18SJ……………………………172
KPZ-JK213J……………………………172
KPZ-JK214J……………………………172
KPZ-JK21LJ……………………………172
KPZ-JK21SJ……………………………172
KRM-430………………………………99
KRM-430G……………………………99
KS-102S………………………………277
KS-27S…………………………………277
KS-48S…………………………………277
KS-92S…………………………………277
KSC-1150………………………………366
KSC-900………………………………366
KSC-B925………………………………366
KSC-C1150……………………………366
KSC-I250………………………………366
KSC-K10………………………………366
KSC-K20………………………………366
KSC-K30………………………………366
KSC-M90………………………………366
KSL-C206………………………………283
KSL-C306………………………………283
KSL-C406………………………………283
KSW-A3………………………………281
KSW-A4………………………………281
KSW-B4………………………………281
KTB-1161………………………………357
KTB-1498………………………………357
KTL-451………………………………297
KTL-452………………………………297
KTZ-1545H……………………………226
KTZ-1545HSE…………………………226
KTZ-1560H……………………………226
KTZ-1560HSE…………………………226
KTZ-1845……………………………225
KTZ-1845H……………………………226
KTZ-1845HSE…………………………226
KTZ-1845SE…………………………225
KTZ-1860……………………………225
KTZ-1860H……………………………226
KTZ-1860HSE…………………………226
KTZ-1860SE…………………………225
KTZ-L1545H…………………………226
KTZ-L1545HSE………………………226
KTZ-L1560H…………………………226
KTZ-L1560HSE………………………226
KTZ-L1845H…………………………226
KU-60…………………………………297
KU-75…………………………………297
KUMI-350F……………………263・365
KUMI-350H……………………263・365
KUMI-450F……………………………261
KUMI-450H……………………………260
KUMI-450T……………………………260
KUMI-900F……………………………261
KUMI-900H……………………………260
KUMI-900T……………………………260
KVO102………………………………276
KVO27…………………………………276
KVO48…………………………………276
KVO92…………………………………276
KVP-60…………………………………139
KVP-90…………………………………139
KVT-1260……………………………248
KY-B300………………………………95
KY-S300………………………………95
KYB-B300………………………………95
KYB-S300………………………………95
LL01B……………………………………353
L01W……………………………………353
L02B……………………………………353
L02TB…………………………………353
L02TW…………………………………353
L02W……………………………………353
L03B……………………………………353
L03W……………………………………353
LCT-1460………………………………294
LCT-760………………………………294
LCT-C600………………………………294
LDC-1840-TOP………………………141
LDC-9040-TOP………………………141
LDC-AJ…………………………………137
LDC-B90………………………………140
LDC-H107……………………………137
LDC-H127……………………………137
LDC-H147……………………………137
LDC-H90N……………………………140
LDC-H90R……………………………140
LDC-H90S………………………………140
LDC-K107-R2…………………………136
LDC-K107-R3…………………………136
LDC-K127-R2…………………………136
LDC-K127-R3…………………………136
LDC-L127B……………………………135
LDC-L127W…………………………135
LDC-R147-LR22………………………137
LDC-R147-LR23………………………137
LDC-R147-LR33………………………137
LDC-R167-LR22………………………137
LDC-R167-LR23………………………137
LDC-R167-LR33………………………137
LDC-TP1270…………………135・139
LDC-WD2……………………………137
LDC-WD3……………………………137
LKC-580………………………………245
LM1……………………………………82
LS-600N………………………………351
LS-600S…………………………………351
LZ-1500………………………………265
LZ-1800………………………………265
LZS-1500………………………………265
LZS-1800………………………………265
MMAC-25…………………107・108・109
MACZA…………………………………391
MACZB…………………………………391
MC-840BR……………………127・344
MC-840NA……………………127・344
MEO-305………………………109・391
MG-140H………………………………96
MG-140L………………………………96
MK-480…………………………109・391
MMP-73………………………………390
MMR-2HM……………………………390
MMR-2M………………………………390
MP-1206A……………………………156
MP-1206AB……………………………157
MP-1207A……………………………156
MP-1207AB……………………………157
MP-1208A……………………………156
MP-1208AB……………………………157
MP-1209A……………………………156
MP-1209AB……………………………157
MP-1209F……………………156・157
MP-1209U……………………………156
MP-1209UB…………………………157
MP-1212A……………………………156
MP-1212AB……………………………157
MP-1212F……………………156・157
MP-1212U……………………………156
MP-1212UB…………………………157
MP-1506A……………………………156
MP-1506AB……………………………157
MP-1507A……………………………156
MP-1507AB……………………………157
MP-1508A……………………………156
MP-1508AB……………………………157
MP-1509A……………………………156
MP-1509AB……………………………157
MP-1509F……………………156・157
MP-1509FAR…………………………156
MP-1509U……………………………156
MP-1509UAR…………………………156
MP-1509UARB………………………157
MP-1509UB…………………………157
MP-1512A……………………………156
MP-1512AB……………………………157
MP-1512F……………………156・157
MP-1512U……………………………156
MP-1512UB…………………………157
MP-1806A……………………………156
MP-1806AB……………………………157
MP-1809A……………………………156
MP-1809AB……………………………157
MP-1809F……………………156・157
MP-1809FAR…………………………156
MP-1809U……………………………156
MP-1809UAR…………………………156
MP-1809UARB………………………157
MP-1809UB…………………………157
MP-1812A……………………………156
MP-1812AB……………………………157
MP-1812F……………………156・157
MP-1812U……………………………156
MP-1812UB…………………………157
MP-2J…………………………158・160
MP-3J…………………………158・160
MP-4J… ………………………158・160
MP-AJ……………………153・158・160
MP-F……………………………158・160
MP-FK…………………………158・160
MP-H……………………………153・158
MP-J……………………………153・158
MP-JK12………………………………158
MP-JK15………………………………158
MP-JK18………………………………158
MP-K………………………153・158・160
MPB-1206A……………………………151
MACZC…………………………………391
MB-1530………………………272・394
MB-1830………………………272・394
MPB-1206AB…………………………152
MPB-1207A……………………………151
MPB-1207AB…………………………152
KTZ-L1845HSE………………………226
MC-510BR……………………128・345
MPB-1208A……………………………151
KPZ-B100………………………………173
KPZ-B75………………………………173
KPZ-BE…………………………………173
KTZ-L1860H…………………………226
KTZ-L1860HSE………………………226
KU-45…………………………………297
MC-510NA……………………128・345
MC-620BR……………………126・343
MC-620NA……………………126・343
MPB-1208AB…………………………152
405
MPB-1209A……………………………151
MPB-1209AB…………………………152
MPB-1209F……………………151・152
MPB-1209U…………………………151
MPB-1209UB…………………………152
MPB-1212A……………………………151
MPB-1212AB…………………………152
MPB-1212F……………………151・152
MPB-1212U…………………………151
MPB-1212UB…………………………152
MPB-1506A……………………………151
MPB-1506AB…………………………152
MPB-1507A……………………………151
MPB-1507AB…………………………152
MPB-1508A……………………………151
MPB-1508AB…………………………152
MPB-1509A……………………………151
MPB-1509AB…………………………152
MPB-1509F……………………151・152
MPB-1509FAR………………………151
MPB-1509U…………………………151
MPB-1509UAR………………………151
MPB-1509UARB……………………152
MPB-1509UB…………………………152
MPB-1512A……………………………151
MPB-1512AB…………………………152
MPB-1512F……………………151・152
MPB-1512U…………………………151
MPB-1512UB…………………………152
MPB-1806A……………………………151
MPB-1806AB…………………………152
MPB-1809A……………………………151
MPB-1809AB…………………………152
MPB-1809F……………………151・152
MPB-1809FAR………………………151
MPB-1809U…………………………151
MPB-1809UAR………………………151
MPB-1809UARB……………………152
MPB-1809UB…………………………152
MPB-1812A……………………………151
MPB-1812AB…………………………152
MPB-1812F……………………151・152
MPB-1812U…………………………151
MPB-1812UB…………………………152
MPB-2J…………………………………153
MPB-3J…………………………………153
MPB-4J…………………………………153
MPB-F…………………………………153
MPB-FK…………………………………153
MPB-JK12……………………………153
MPB-JK15……………………………153
MPB-JK18……………………………153
MR-450…………………………………386
MR-550…………………………………384
MR-650……………………384・386・387
MR-700…………………………386・387
MR-750……………………384・385・387
MR-80…………………………………304
MR-800…………………………384・385
MR-850…………………………384・385
MR-900…………………………………385
MRS-13…………………………307・308
MUD-640………………………………289
NNDP-110………………………………282
NDP-210………………………………282
NDP-310………………………………282
NDS-100………………………………295
NDS-BP1………………………………295
NDS-CS1………………………………295
NDS-FP1………………………………295
NDS-RR1………………………………295
NDS-SF1………………………………295
NDW-19L………………………………147
NDW-45BT……………………………147
NFM-50………………………………285
NFW-460………………………………146
NFW-463………………………………146
NFW-660………………………………146
NFW-663………………………………146
NFW-860………………………………146
NFW-863………………………………146
NKBP-C204……………………………282
NOPC…………………………………288
NOTD-1890…………………………207
NOTD-2412…………………………207
NOTD-3612…………………………207
NOTF-1890……………………………207
NOTF-2412……………………………207
NOTF-3612……………………………207
NOTK-1890……………………………207
NOTK-2412……………………………207
NOTK-3612……………………………207
NPC-C101……………………………288
NPC-C102……………………………288
NPC-C202……………………………288
NPF-C108……………………………283
NPF-C208……………………………283
NPF-C308……………………………283
NPT-BK…………………………………296
NPT-WH………………………………296
NR-1……………………………………289
NR-2……………………………………289
NRSS-450………………………………280
NSP-102C……………………………282
NSP-C202……………………………282
NST-40…………………………………297
NUK-480………………………………288
NUK-B…………………………………288
NUM-50………………………………289
NUM-MT………………………………289
NZ-1……………………………………244
NZ-2……………………………………244
NZ-3……………………………………244
NZ-A1…………………………………243
NZ-A2…………………………………243
NZ-A3…………………………………243
NZH-1…………………………………242
NZH-2…………………………………242
NZH-3…………………………………242
OOCP-1G………………………………400
OKT……………………………………377
OKW-35………………………………146
OKW-36………………………………146
OP-CPU…………………………………95
OP-CS…………………………………95
OP-HP…………………………………95
OP-NY…………………………………95
OT-1260………………………………249
OT-4560………………………………249
OTC-1845B……………………………383
OTC-1845S……………………………383
OTC-1860B……………………………383
OTC-1860S……………………………383
P
PAN-11…………………………………286
PAN-12…………………………………286
PB-609…………………………………293
PB-912…………………………………293
PB-918…………………………………293
PBK-609………………………………293
PBK-912………………………………293
PBK-918………………………………293
PCP-102…………………153・158・166
PH-5……………………………………289
PHN-1200…………………68・299・322
PLC-120H………………………………97
PLC-120L………………………………97
PLK-11…………………………………286
PMB-609………………………………293
PMB-912………………………………293
PMB-918………………………………293
PMR-3B……………………………67・143
PMS-609………………………………293
PMS-912………………………………293
PMS-918………………………………293
PNT-1845S……………………………377
PNT-1860S……………………………377
PPN-920………………………………322
PRO-4B……………………………66・142
PRO-4W…………………………66・142
PSA-1207A……………………………167
PSA-1209A……………………………167
PSA-1210A……………………………167
PSA-1212A……………………………167
PSA-1507A……………………………167
PSA-1509A……………………………167
PSA-1509F……………………………167
PSA-1510A……………………………167
PSA-1512A……………………………167
PSA-1512F……………………………167
PSA-1809A……………………………167
PSA-1810A……………………………167
PSA-1812A……………………………167
PSA-2J…………………………………168
PSA-F……………………………………168
PSA-FK…………………………………168
PSA-JK12………………………………168
PSA-JK15………………………………168
PSA-JK18………………………………168
PSA-MJ…………………………………168
PSA-RF…………………………………168
PSB-1207A……………………………165
PSB-1209A……………………………165
PSB-1210A……………………………165
PSB-1212A……………………………165
PSB-1507A……………………………165
PSB-1509A……………………………165
PSB-1509F……………………………165
PSB-1510A……………………………165
PSB-1512A……………………………165
PSB-1512F……………………………165
PSB-1809A……………………………165
PSB-1810A……………………………165
PSB-1812A……………………………165
PSB-2J…………………………………166
PSB-JK12………………………………166
PSB-JK15………………………………166
PSB-JK18………………………………166
PSB-MJ…………………………………166
Q
QSB-1510……………………………149
QSB-1810T……………………………149
R
RD-42…………………………………259
RD-42C…………………………………259
RD-43…………………………………259
RD-44…………………………………259
RD-52…………………………………258
RD-52C…………………………………258
RD-53…………………………………259
RD-54…………………………………259
RKA-410………………………………308
RKW-455………………………………308
RMS-345B……………………………392
RMS-345S……………………………392
RN-8……………………………………228
RO-N600………………………………257
RO-NR600……………………………257
RO-S1200……………………………256
RO-S1800……………………………256
RO-S600………………………………256
RO-SC90………………………………257
RO-SIR90………………………………257
RO-SL90………………………………257
RO-SOR90……………………………257
RO-SR90………………………………257
ROB-1500……………………………393
ROB-1800……………………………393
ROU-3660M…………………………384 ROU-3660T……………………………384 ROU-3676M…………………………384 ROU-3676T……………………………384 ROU-4060M…………………………384 ROU-4060T……………………………384 ROU-4076M…………………………384 ROU-4076T……………………………384 ROU-4560M…………………………384 ROU-4560T……………………………384 ROU-4576M…………………………384 ROU-4576T……………………………384 ROU-5060M…………………………384 ROU-5060T……………………………384 ROU-5076M…………………………384 ROU-5076T……………………………384 RSC-4060M……………………………387
RSC-4060T……………………………387 RSC-4560M……………………………387 RSC-4560T……………………………387 RSC-5060M……………………………387
RSC-5060T……………………………387
RST-380………………………………393
RWZ-1845……………………………227
RWZ-1860……………………………227
RYS-3638M……………………………386 RYS-3638T……………………………386 RYS-4038M……………………………386 RYS-4038T……………………………386
RYS-4538M……………………………386 RYS-4538T……………………………386
S
S-DB………………………302・311・363 S-LB……………………………311・313
S-OB……………………………311・363 S-SB……………………………311・363 S-SK……………………………311・363 SC-20……………………………120・392 SCT-6545………………………………389
SDP-1800………………………145・399
SFC-2BS………………………………390
SFC-2M…………………………125・390
SFC-2ST………………………………390
SFC-2T…………………………125・390 SFIDA…………………………………108
SFIDA-B…………………………………107
SFIDA-C1………………………………106
SFS-430F………………………………131
SHE-04…………………………………320
SHE-06…………………………………320
SHM-1545……………………………214
SHM-1560……………………………214
SHM-1845……………………………214
SHM-1860……………………………214
SHM-JM1545…………………………214
SHM-JM1560…………………………214
SHM-JM1845…………………………214
SHM-JM1860…………………………214
SI-4545…………………………384・386 SI-5050…………………………384・387
SI-5555…………………………………386 SI-6060…………………………386・387 SI-6565…………………………384・385 SI-7070……………………384・385・387
SI-7575…………………………384・385
SI-8585…………………………………385
SIK-1875VA……………………………239
SIK-1875VM…………………………239
SK-1……………………………………303
SKC-01…………………………………86
SKD-6045……………………………397
SKN-1809SK…………………………187
SKN-1809SK+SPJ-0001……………187
SKN-1812SK…………………………187
SKN-1812SK+SPJ-0001……………187
SL-AL…………………………… 80・81・86
SL-AR……………………………………86
SL-HG……………………………………86
406
SMP-1506MP…………………………177
SMP-1506PC…………………………177
SMP-1509AR…………………177・395
SMP-1509MP…………………………177
SMP-1509PC…………………………177
SMP-1806MP…………………………177
SMP-1806PC…………………………177
SMP-1809AR…………………177・395
SMP-1809MP…………………………177
SMP-1809PC…………………………177
SMP-3CL………………………………178
SMP-3J…………………………………178
SMP-3PC………………………………178
SMP-4J…………………………………178
SMP-F…………………………178・395
SMP-FK…………………………178・395
SMP-LJ…………………………………178
SMP-SJ…………………………………178
SO-1845B……………………………382
SO-1845BB……………………………382
SO-1845S………………………………382
SO-1845SB……………………………382
SO-1860B……………………………382
SO-1860BB……………………………382
SO-1860S………………………………382
SO-1860SB……………………………382
SPB-1800W……………………………352
SPB-600W……………………………352
SPC-F12………………………………296
SPC-F8…………………………………296
SPC-K12………………………………296
SPC-K9…………………………………296
SPJ-0001………………………………187
SSD-1860………………………………393
SSD-1860ST…………………………393
SSW-A3………………………………281
SSW-A4………………………………281
SSW-B4…………………………………281
ST-32TN………………………………133
STG-200B………………………………396
STG-200G……………………………396
STG-400B………………………………396
STG-400G……………………………396
STG-600B………………………………396
STG-600G……………………………396
STO-1845……………………………382
STO-1845B……………………………382
STO-1860……………………………382
STO-1860B……………………………382
STP-HO…………………………………395
SUP-1245WWK………………………229
SUP-1260WWK………………………229
SUP-1275WWK………………………229
SUP-1545WWK………………………229
SUP-1560WWK………………………229
SUP-1575WWK………………………229
SUP-1845WWK………………………229
SUP-1860WWK………………………229
SUP-1875WWK………………………229
SUP-1890WWK………………………229
SUP-945WWK………………………229
SUP-960WWK………………………229
SUP-975WWK………………………229
SUPH-1245WWK……………………229
SUPH-1260WWK……………………229
SUPH-1275WWK……………………229
SUPH-1545WWK……………………229
SUPH-1560WWK……………………229
SUPH-1575WWK……………………229
SUPH-1845WWK……………………229
SUPH-1860WWK……………………229
SUPH-1875WWK……………………229
SUPH-1890WWK……………………229
SUPH-945WWK………………………229
SUPH-960WWK………………………229
SUPH-975WWK………………………229
TT-30Bメッキ……………………………301
T-30B塗装………………………………301
T-30Nメッキ……………………………301
T-30N塗装……………………………301
T-30Rメッキ……………………………301
T-30R塗装………………………………301
T-30Tメッキ……………………………301
T-30T塗装………………………………301
T-30Wメッキ…………………………301
T-30W塗装……………………………301
T-45Bメッキ……………………………301
T-45B塗装………………………………301
T-45Nメッキ……………………………301
T-45N塗装……………………………301
T-45Rメッキ……………………………301
T-45R塗装………………………………301
T-45Tメッキ……………………………301
T-45T塗装………………………………301
T-45Wメッキ…………………………301
T-45W塗装……………………………301
T-60Bメッキ……………………………301
T-60B塗装………………………………301
T-60Nメッキ……………………………301
T-60N塗装……………………………301
T-60Rメッキ……………………………301
T-60R塗装………………………………301
T-60Tメッキ……………………………301
T-60T塗装………………………………301
T-60Wメッキ…………………………301
T-60W塗装……………………………301
TA-1260B……………………………249
TA-1575B……………………………210
TA-1890B……………………………210
TA-2190B……………………………210
TBY-609………………………………293
TBY-912………………………………293
TBY-918………………………………293
TCH-B…………………………………123
TCH-BC…………………………………123
TCH-W…………………………………123
TCH-WC………………………………123
TDK-03…………………………………313
TDK-04…………………………………313
TEM-1209……………………………188
TEM-1809……………………………188
TEM-MG………………………………188
TEP-JK…………………………………188
TEP-RB…………………………………188
TEP-SB…………………………………188
TEY-1209………………………………189
TEY-1809………………………………189
TEY-LHK3………………………………189
TJ-OPSHIKI 17………………………137
TJ-OPSHIKI S…………………………137
TJ-OPSHIKI Z…………………………137
TKB-W609……………………………293
TKB-W912……………………………293
TKB-W918……………………………293
TM-1690… ……………………………340
TM-1890………………………………340
TMO-N…………………………………132
TMO-NC………………………………132
TMO-S…………………………………132
TMO-SC………………………………132
TPA-A1509B…………………………191
TPA-A1809B…………………………191
TPA-FK…………………………………166
TPA-M1509B…………………………192
TPA-M1809B…………………………192
TPA-R1509B…………………………191
TPA-R1809B…………………………191
TPA-RF…………………………………166
TPA-V1509B…………………………192
TPA-V1809B…………………………192
TU-1845………………………………224
TU-1845SE……………………………224
TU-1845T……………………………224
TU-1845TSE…………………………224
TU-1860………………………………224
TU-1860SE……………………………224
TU-1860T……………………………224
TU-1860TSE…………………………224
TUD-34Y………………………………291
TUD-36Y………………………………291
TWB-W609……………………………293
TWB-W912……………………………293
TWB-W918……………………………293
UUC-900…………………………………389
UNC-H1260T…………………321・388
UNC-H1570T…………………321・388
UNC-H1870T…………………321・388
UNC-L1260T…………………………388
UNC-L1570T…………………………388
UNC-L1870T…………………………388
VVAHK-1875……………………………213
VAHK-1875S…………………………213
VAHK-1890……………………………213
VAHK-1890S…………………………213
VAHM-1545…………………………217
VAHM-1845…………………………217
VAHM-1860…………………………217
VAHM-6545…………………………218
VAHM-JM1545………………………217
VAHM-JM1845………………………217
VAHM-JM1860………………………217
VAHM-JM6545………………………218
VCFH-T60B……………………………235
VCFH-T60S……………………………235
VCFL-T80B……………………………235
VCFL-T80S……………………………235
VCH-AR…………………………………333
VCH-ARW……………………………333
VCH-DE…………………………………332
VCH-DEZ………………………………332
VCH-RC…………………………………333
VCH-RCZ………………………………333
VCH-SO………………………………333
VCH-SOZ………………………………333
VCH-UK………………………………332
VCH-UKZ………………………………332
VFTR-1290N…………………………338
VFTR-1590N…………………………338
VFTR-1690N…………………………338
VFTR-1890N…………………………338
VHAC-1290 …………………………337
VHAC-1590 …………………………337
VHAC-1690 …………………………337
VHAC-1890 …………………………337
VHAJ-K1290…………………………337
VHAJ-K1590…………………………337
VHAJ-K1690…………………………337
VHAJ-K1890… ………………………337
VHAK-K1290 …………………………337
VHAK-K1590 …………………………337
VHAK-K1690 …………………………337
VHAK-K1890 …………………………337
VHCT-1245……………………………329
VHCT-1545……………………………329
VHCT-845……………………………329
VHCT-C500……………………………329
VHCT-RS6050………………………329
VKD-1250H……………………………327
VKD-1250L……………………………327
VKS-1575………………………………212
VKS-1875………………………………212
VKS-1890………………………………212
VKS-D1575……………………………212
VKS-D1890……………………………212
VKT-1845B……………………………222
VKT-1845S……………………………222
VKT-1860B……………………………222
VKT-1860S……………………………222
VKT-1890B……………………………222
VKT-1890S……………………………222
VKT-TN1245BBSE……………221・381
VKT-TN1245BCSE…………………380
VKT-TN1245BUSE…………………381
VKT-TN1245GBSE…………………381 VKT-TN1245GCSE…………………380
VKT-TN1245SBSE……………………381
VKT-TN1245SCSE……………………380
VKT-TN1245SUSE…………………381
VKT-TN1260BBSE……………………381
VKT-TN1260BCSE…………………380
VKT-TN1260BUSE…………………381
VKT-TN1260GBSE…………………381
VKT-TN1260GCSE…………………380
VKT-TN1260SBSE……………………381
VKT-TN1260SCSE……………………380
VKT-TN1260SUSE…………………381
VKT-TN1545BBSE……………………381
VKT-TN1545BCSE…………………380
VKT-TN1545BUSE…………………381
VKT-TN1545GBSE…………………381
VKT-TN1545GCSE…………………380
VKT-TN1545SBSE……………………381
VKT-TN1545SCSE……………………380
VKT-TN1545SUSE…………………381
VKT-TN1560BBSE……………………381
VKT-TN1560BCSE…………………380
VKT-TN1560BUSE…………………381
VKT-TN1560GBSE…………………381
TPA-W1509B…………………………190
VKD-9050H……………………………327
VKD-9050L……………………………327
VKDK-1250……………………………327
SW-480………………………………269
TPA-W1809B…………………………190
TSN-ST…………………………………132
TT-900…………………………233・398
VKDK-9050……………………………327
VKS-1260………………………………212
VKS-1275………………………………212
VKT-TN1560GCSE…………………380 VKT-TN1560SBSE……………………381 VKT-TN1560SCSE……………………380 VKT-TN1560SUSE…………………381 VKT-TN1845BBSE……………………381 VKT-TN1845BCSE…………………380 VKT-TN1845BSSE……………………380 VKT-TN1845BUSE…………………381 VKT-TN1845GBSE…………………381 VKT-TN1845GCSE…………………380 VKT-TN1845GSSE…………………380 VKT-TN1845SBSE……………………381 VKT-TN1845SCSE……………………380 VKT-TN1845SSSE……………………380 VKT-TN1845SUSE…………………381 VKT-TN1860BBSE……………………381 VKT-TN1860BCSE…………………380 VKT-TN1860BSSE……………………380 VKT-TN1860BUSE…………………381 VKT-TN1860GBSE…………………381 VKT-TN1860GCSE…………………380 VKT-TN1860GSSE…………………380 VKT-TN1860SBSE……………………381 VKT-TN1860SCSE……………………380 VKT-TN1860SSSE……………………380 VKT-TN1860SUSE…………………381 VKT-TN1890BBSE……………………381 VKT-TN1890BCSE…………………380 VKT-TN1890BSSE……………………380 VKT-TN1890GBSE…………………381 VKT-TN1890GCSE…………………380 VKT-TN1890GSSE…………………380 VKT-TN1890SBSE……………………381 VKT-TN1890SCSE……………………380 VKT-TN1890SSSE……………………380 VKT-TN6545BBSE……………………221 VKT-TN9045BBSE……………221・381 VKT-TN9045BCSE…………………380
407
VKT-TN9045BUSE…………………381
VKT-TN9045GBSE…………………381
VKT-TN9045GCSE…………………380
VKT-TN9045SBSE……………………381
VKT-TN9045SCSE……………………380
VKT-TN9045SUSE…………………381
VKT-TN9060BBSE……………………381
VKT-TN9060BCSE…………………380
VKT-TN9060BUSE…………………381
VKT-TN9060GBSE…………………381
VKT-TN9060GCSE…………………380
VKT-TN9060SBSE……………………381
VKT-TN9060SCSE……………………380
VKT-TN9060SUSE…………………381
VKT-TN9090BBSE……………………381
VKT-TN9090BCSE…………………380
VKT-TN9090GBSE…………………381
VKT-TN9090GCSE…………………380
VKT-TN9090SBSE……………………381
VKT-TN9090SCSE……………………380
VLCT-1270……………………………331
VLCT-1570……………………………331
VLCT-870………………………………331
VLCT-C800……………………………331
VLCT-KP1270…………………………331
VLCT-KP870…………………………331
VLCT-RP1270…………………………331
VLCT-RP870…………………………331
VLTC-L1575…………………………220
VLTC-L1890…………………………220
VMP-1806A…………………………160
VMP-1809A…………………………160
VMP-1812A…………………………160
VMRT-1690 …………………………336
VMRT-1890 …………………………336
VMRT-K1690 …………………………336
VMRT-K1890 …………………………336
VMRT-W1690 ………………………336
VMRT-W1890 ………………………336
VNR-66K………………………………183
VNR-88K………………………………183
VNT-1845……………………………377
VNT-1860… …………………………377
VRK-F1690 ……………………………339
VRK-F1890 ……………………………339
VSL-66…………………………………397
VSL-67…………………………………397
VSL-68…………………………………397
VT-30B…………………………………300
VT-45B…………………………………300
VTA-1575B……………………………210
VTA-1890B……………………………210
VTA-2190B……………………………210
VTM-1690 ……………………………340
VTM-1890 ……………………………340
VTT-440………………………………329
VWLT-1010…………………………335
VWLT-9060…………………………335
VWLT-9090…………………………335
VWLT-K9060…………………………335
VWLT-K9090…………………………335
VWLT-W1010………………………335
VWLT-W9060………………………335
VWLT-W9090………………………335
VWST-9055…………………………341
WWB3826/WB3827/WB3828…… 361
WB3882/WB3883/WB3884/…
WB3885/WB3886/WB5212…… 361
WB5134………………………………360
WB5135………………………………360
WB5238/WB5239/WB5240…… 361
WBC-9045B…………………………290
WBD-V02……………………………307
WBD-VHD……………………………307
WBS-1209RF…………………290・399
WBS-1809RF…………………290・399
WC-2P…………………………………349
WE-CT5050…………………………359
WE-CT5050-MAT-A…………………359
WE-CT5050-MAT-B…………………359
WE-CT5050-MAT-C…………………359
WE-CT5050+WE-CT5050-MAT-A/ MAT-B/MAT-C………359
WE-K1…………………………………358
WE-SC1………………………………355
WG-51…………………………………356
WG-53…………………………………356
WGN-3…………………………………313
WH-345………………………………292
WH-456………………………………292
WH-609………………………………292
WH-612………………………………292
WH-912………………………………292
WH-918………………………………292
WH-M456……………………………292
WH-M456Y……………………………292
WH-M609……………………………292
WH-M609Y……………………………292
WH-M912……………………………292
WH-M912Y……………………………292
WH-M918……………………………292
WH-M918Y……………………………292
WHP-1218……………………………290
WHP-912………………………………290
WHP-918………………………………290
WHP-R1218…………………………290
WHP-R912……………………………290
WHP-R918……………………………290
WJ-IN2…………………………137・205
WJ-IN3…………………………137・205
WL-1845………………………………225
WL-1845SE……………………………225
WL-1845T……………………………225
WL-1845TSE…………………………225
WL-1860………………………………225
WL-1860SE……………………………225
WL-1860T……………………………225
WL-1860TSE…………………………225
WLB-1845……………………………224
WLB-1845SE…………………………224
WLB-1845T……………………………224
WLB-1845TSE………………………224
WLB-1860……………………………224
WLB-1860SE…………………………224
WLB-1860T……………………………224
WLB-1860TSE………………………224
WS-345………………………………292
WS-456………………………………292
WS-609………………………………292
WS-912………………………………292
WS-918………………………………292
WUD-55B……………………………291
WUD-GEL……………………………291
WUD-PT………………………………291
YY-OB……………………………………312
YA4PT-109N…………………………147
YA4PT-118N…………………………147
YA4PT-209N…………………………147
YA4PT-218N…………………………147
YKT-1245………………………………223
YKT-1245SE…………………………223
YKT-1260………………………………223
YKT-1260SE…………………………223
YKT-1545………………………………223
YKT-1545SE…………………………223
YKT-1560………………………………223
YKT-1560SE…………………………223
YKT-1845………………………………223
YKT-1845SE…………………………223
YKT-1860………………………………223
YKT-1860SE…………………………223
YKT-1890………………………………223
YKT-1890SE…………………………223
YKT-TN1245BBSE……………………379
YKT-TN1245BCSE……………………378
YKT-TN1245BUSE…………………379
YKT-TN1245GBSE…………………379
YKT-TN1245GCSE…………………378
YKT-TN1245SBSE……………………379
YKT-TN1245SCSE……………………378
YKT-TN1245SUSE……………………379
YKT-TN1260BBSE……………………379
YKT-TN1260BCSE……………………378
YKT-TN1260BUSE…………………379
YKT-TN1260GBSE…………………379
YKT-TN1260GCSE…………………378
YKT-TN1260SBSE……………………379
YKT-TN1260SCSE……………………378
YKT-TN1260SUSE……………………379
YKT-TN1545BBSE……………………379
YKT-TN1545BCSE……………………378
YKT-TN1545BUSE…………………379
YKT-TN1545GBSE…………………379
YKT-TN1545GCSE…………………378
YKT-TN1545SBSE……………………379
YKT-TN1545SCSE……………………378
YKT-TN1545SUSE……………………379
YKT-TN1560BBSE……………………379
YKT-TN1560BCSE……………………378
YKT-TN1560BUSE…………………379
YKT-TN1560GBSE…………………379
YKT-TN1560GCSE…………………378
YKT-TN1560SBSE……………………379
YKT-TN1560SCSE……………………378
YKT-TN1560SUSE……………………379
YKT-TN1845BBSE……………………379
YKT-TN1845BCSE……………………378
YKT-TN1845BSSE……………………378
YKT-TN1845BUSE…………………379
YKT-TN1845GBSE…………………379
YKT-TN1845GCSE…………………378
YKT-TN1845GSSE……………………378
YKT-TN1845SBSE……………………379
YKT-TN1845SCSE……………………378
YKT-TN1845SSSE……………………378
YKT-TN1845SUSE……………………379
YKT-TN1860BBSE……………………379
YKT-TN1860BCSE……………………378
YKT-TN1860BSSE……………………378
YKT-TN1860BUSE…………………379
YKT-TN1860GBSE…………………379
YKT-TN1860GCSE…………………378
YKT-TN1860GSSE……………………378
YKT-TN1860SBSE……………………379
YKT-TN1860SCSE……………………378
YKT-TN1860SSSE……………………378
YKT-TN1860SUSE……………………379
YKT-TN1890BBSE……………………379
YKT-TN1890BCSE……………………378
YKT-TN1890BSSE……………………378
YKT-TN1890GBSE…………………379
YKT-TN1890GCSE…………………378
YKT-TN1890GSSE……………………378
YKT-TN1890SBSE……………………379
YKT-TN1890SCSE……………………378
YKT-TN1890SSSE……………………378
YKT-TN9045BBSE……………………379
YKT-TN9045BCSE……………………378
YKT-TN9045BUSE…………………379
YKT-TN9045GBSE…………………379
YKT-TN9045GCSE…………………378
YKT-TN9045SBSE……………………379
YKT-TN9045SCSE……………………378
YKT-TN9045SUSE……………………379
YKT-TN9060BBSE……………………379
YKT-TN9060BCSE……………………378
YKT-TN9060BUSE…………………379
YKT-TN9060GBSE…………………379
YKT-TN9060GCSE…………………378
YKT-TN9060SBSE……………………379
YKT-TN9060SCSE……………………378
YKT-TN9060SUSE……………………379
YKT-TN9090BBSE……………………379
YKT-TN9090BCSE……………………378
YKT-TN9090GBSE…………………379
YKT-TN9090GCSE…………………378
YKT-TN9090SBSE……………………379
YKT-TN9090SCSE……………………378
YKZ-1245……………………………227
YKZ-1245H……………………………227
YKZ-1245HSE…………………………227
YKZ-1245SE…………………………227
YKZ-1260……………………………227
YKZ-1260H……………………………227
YKZ-1260HSE…………………………227
YKZ-1260SE…………………………227
YKZ-1545……………………………227
YKZ-1545H……………………………227
YKZ-1545HSE…………………………227
YKZ-1545SE…………………………227
YKZ-1560……………………………227
YKZ-1560H……………………………227
YKZ-1560HSE…………………………227
YKZ-1560SE…………………………227
YKZ-1845……………………………227
YKZ-1845H……………………………227
YKZ-1845HSE…………………………227
YKZ-1845SE…………………………227
YKZ-1860……………………………227
YKZ-1860H……………………………227
YKZ-1860HSE…………………………227
YKZ-1860SE…………………………227
YSC01…………………………………85
YSC01-AR………………………………85
ZZC-590…………………………………247
ZCL-590………………………………247
ZSB-1800………………………………312
ZSB-1650………………………………312
ZZ-1500………………………………265
ZZ-1800………………………………265
ZZW-1500……………………………265
ZZW-1800……………………………265
かな(五十音順)
ドーナツイス……………………………133 丸イス……………………………133・392 山中サイドテーブル……………………249 山中センターテーブル…………………249 楢-66……………………………185・395 楢-66C…………………………………184 楢-66CB………………………………184 楢-88……………………………185・395 楢-88C…………………………………184 楢-88CB………………………………184
408
製品の取り扱いについて
◆製品全般
•製品の上に立ったり飛び跳ねたり、不安定な姿勢で掛けたり しないで下さい。
また、踏み台以外のものを踏み台代わりに使用しないで下さい。
バランスをくずしけがの原因となります。
•製品を移動する際は引きずったり、落としたり、倒したりしない ようにしてください。
•引き出しなどの収納がある製品の場合は、一度中のものを出して から移動するようにしてください。
•製品の上に加熱した鍋、やかん等を直接置かないでください。
変形や変色、破損の原因になります。
•製品の分解、改造、不当な修理をしないで下さい。火災、ケガ などの事故、故障の原因となります。また、天災時の不可抗力 やお客様のお取り扱上の不注意、不当な修理、改造による故障、 損壊、破損と判明した場合、保証対象外となります。
•製品にマニキュアや除光液などの有機溶剤が付着すると塗装が 剥がれたり変色したりすることがありますのでご注意ください。
◆家具の設置場所
•高温、多湿の部屋では、空気が滞留するとカビやダニが発生 しやすくなり、健康を害することがあります。家具の裏側に 空気が流れるよう壁から少し(10cm 程度) 離したり、部屋の 換気をしてください。
•直射日光や熱、冷房暖気の風が直接当たらないように設置して ください。家具が歪んだり、変色したりする原因となる場合 があります。
•床に設置する場合、水平に保つように設置して下さい。ガタ ついたり、歪み、破損の原因となる場合があります。
◆換気に関する注意事項
•製品によって、塗装、接着剤のにおいが梱包内でこもっている 場合があります。梱包を開けて作業する際は通気性を良くして 行ってください。
•製品組み立て後、臭いが残る場合は通気性の良い場所でしば らく放置してからご使用ください。
◆電動工具をご使用される場合 •電動工具をご使用になる際には、ネジとビットの規格が合って いない工具穴が潰れてしっかりと締め付けることが出来なく なる可能性があります。
◆保守 / 点検
•取扱金具や固定用ネジ類のあるものは、ネジ、ボルト類にゆるみ が無いか2 3 か月毎に点検し、ゆるみをしっかり締め直して ください。ゆるんだままご使用になりますと製品が壊れてけが をする場合があります。また、製品の移動をした時も点検し ゆるみをしっかりと締め直してください。
●執務用チェア、会議用チェア、ベンチなど •座面の前縁部、外縁部に腰掛けないでください。転倒してケガ などの事故、または、故障の原因となります。
•製品が濡れた状態で使用しないでください。カビや変色の原因 となります。
•イスやベンチの上に立ち上がり、踏み台代わりに使用しないで ください。転倒や転落により、ケガをする恐れがあります。
•スタッキング可能な製品を積み上げる際は、規定以上積み上げ ないでください。くずれてケガをする恐れがあります。
•キャスターやガスシリンダーは消耗部品となりますので、機能 低下や劣化異常が発生しましたら直ちにご使用を控えて部品 の交換等の対応をしてください。
•キャスターチェアをご使用の際は床にあったキャスターをお選び ください。カーペットなどの柔らかい床にはナイロンキャス ター、フローリングなどの硬い床にはポリウレタンキャスター やゴムキャスターが適しています。
●折り畳みいす
•製品の特性上、各部が折り畳む機構になっております。稼動 部に指などを挟まないように注意してください。
•ご使用の際は、完全に広げてからご使用ください。完全に広 げずにご使用になられると指を挟んだり、バランスを崩して 転倒する恐れがあります。
●デスク、収納家具
•移動の際は、中の収納物を一度取り出し、施錠してから持ち 運んでください。床を傷つけたり、製品が倒壊する恐れがあ ります。
•一度に複数の引き出しを出すと重みで転倒する恐れがあります。
•引き出しにものを収納する際は、最下段から収納してください。
上段から収納すると重みで転倒する恐れがあります。
•上段の扉を開いたまま下段の扉の開け閉めをしないでください。 立ち上がった際に頭をぶつけてケガをすることがあります。
•キャスター付デスク・ワゴンを移動させる際は、必ずロック を解除してから移動させてください。キャスターが破損したり 引きずられて床に傷がつく場合があります。
•合鍵の作製ができない製品もございますので、スペアキーは 必ず製品本体とは別の場所に保管し紛失しないようにしてく ださい。
◆木製家具
•天然木は設置場所の温度・湿度等の条件により伸縮を繰り返す ため、製品の部材の間にすき間が生じる場合があります。
•天然木の塗装面に、硬いものを直接置いたり、ものを引きずった りすると表面を傷つけるおそれがありますのでご注意ください。
•塗装面( ラッカー塗装、PU 塗装、オイル仕上げなど) に樹脂 製品やゴム製品を直接置くと、変色やベトツキが生じる場合 がありますので、直接置かないようご注意ください。
•直射日光が当たる場所や暖房器具の熱・冷気が直接当たると ころでのご使用はさけてください。変色・変形・反り・割れ 等の原因になります。
●梱包才数における1才は0.027㎡となります。 ●カタログ掲載の商品は品質改良のため、実物と異なる場合があります。 ●2024年1月1日発行 ●価格3,000円(税抜価格)

MPBシリーズ
パネルU (上部半透明)
MPB-1812U P.151 NEW パネルU (上部半透明)
MPB-1812F P.151 NEW パネルF (全面半透明)
MPBシリーズ 防炎タイプ
MPB-1812AB P.152 パネルA (全面布)
MPB-1512AB P.152 パネルA (全面布)
MPB-1212AB P.152 パネルA (全面布) パネルU (上部透明)
MPB-1209UB P.152 パネルU (上部半透明) MPB-1509UB パネルU (上部半透明) MPB-1812UB P.152 NEW パネルU (上部半透明)
MPB-1212F P.152 NEW パネルF (全面半透明)
MPBシリーズ
パネルU (上部半透明)
MPB-1812U P.151 NEW パネルU (上部半透明)
MPB-1812F P.151 NEW パネルF (全面半透明)
MPBシリーズ 防炎タイプ
MPB-1812AB P.152 パネルA (全面布)
MPB-1512AB P.152 パネルA (全面布)
MPB-1212AB P.152 パネルA (全面布) パネルU (上部透明)
MPB-1209UB P.152 パネルU (上部半透明) MPB-1509UB パネルU (上部半透明) MPB-1812UB P.152 NEW パネルU (上部半透明)
MPB-1212F P.152 NEW パネルF (全面半透明)









































































































































 TPA-R1509B P.191 単体アルミパーティション
TPA-A1809B P.191 単体アルミパーティション
TPA-A1509B P.191 単体アルミパーティション
TPA-V1809B P.192 単体アルミパーティション TPA-V1509B P.192 単体アルミパーティション
TPA-M1809B P.192 単体アルミパーティション
TPA-M1509B P.192 単体アルミパーティション
パーティション
APF-1809F P.193
(安定脚タイプ)
APF-1812FK P.193 アルミパーティション (キャスター脚タイプ) APF-1809FK P.193 アルミパーティション (キャスター脚タイプ)
AA-158 P.194 アコーディオンスクリーン
AXシリーズ
TPA-R1509B P.191 単体アルミパーティション
TPA-A1809B P.191 単体アルミパーティション
TPA-A1509B P.191 単体アルミパーティション
TPA-V1809B P.192 単体アルミパーティション TPA-V1509B P.192 単体アルミパーティション
TPA-M1809B P.192 単体アルミパーティション
TPA-M1509B P.192 単体アルミパーティション
パーティション
APF-1809F P.193
(安定脚タイプ)
APF-1812FK P.193 アルミパーティション (キャスター脚タイプ) APF-1809FK P.193 アルミパーティション (キャスター脚タイプ)
AA-158 P.194 アコーディオンスクリーン
AXシリーズ





























































































































 (長方形) ETZ-1200 P.233 フライト式宴会テーブル
ETZ-K1860 P.233 フライト式宴会テーブル
TT-900 P.233 ターンテーブル
カフェテーブル
ASO-CF750B P.234 カフェテーブル
ASO-CF750W P.234
カフェテーブル
(長方形) ETZ-1200 P.233 フライト式宴会テーブル
ETZ-K1860 P.233 フライト式宴会テーブル
TT-900 P.233 ターンテーブル
カフェテーブル
ASO-CF750B P.234 カフェテーブル
ASO-CF750W P.234
カフェテーブル










































 応接ソファ
NZH-1 P.242 応接ソファ
NZH-2 P.242 応接ソファ NZH-3 P.242 応接ソファ NZ-A1 P.243 応接ソファ NZ-A2 P.243 応接ソファ NZ-A3 P.243 応接ソファ
NZ-1 P.244 応接ソファ
NZ-2 P.244 応接ソファ NZ-3 P.244 応接ソファ
LKC-580 P.245 NEW ラウンジチェア
応接イス
KOT-580 P.246 応接イス KOT-1080 P.246 応接イス
ZCL-590 P.247 キャスターチェア ZC-590 P.247 キャスターチェア
応接テーブル
ASO-OT1260 P.248 NEW 抗ウイルスセンターテーブル KVT-1260 P.248 センターテーブル
OT-1260 P.249 センターテーブル
OT-4560 P.249 サイドテーブル
山中センターテーブル P.249 センターテーブル
TA-1260B P.249 センターテーブル
テーブル
応接ソファ
NZH-1 P.242 応接ソファ
NZH-2 P.242 応接ソファ NZH-3 P.242 応接ソファ NZ-A1 P.243 応接ソファ NZ-A2 P.243 応接ソファ NZ-A3 P.243 応接ソファ
NZ-1 P.244 応接ソファ
NZ-2 P.244 応接ソファ NZ-3 P.244 応接ソファ
LKC-580 P.245 NEW ラウンジチェア
応接イス
KOT-580 P.246 応接イス KOT-1080 P.246 応接イス
ZCL-590 P.247 キャスターチェア ZC-590 P.247 キャスターチェア
応接テーブル
ASO-OT1260 P.248 NEW 抗ウイルスセンターテーブル KVT-1260 P.248 センターテーブル
OT-1260 P.249 センターテーブル
OT-4560 P.249 サイドテーブル
山中センターテーブル P.249 センターテーブル
TA-1260B P.249 センターテーブル
テーブル


































































































































































































































































































































































 VFTR-1590N P.338
抗ウイルス福祉用 テーブル
VRK-F1890 P.339
抗ウイルス跳ね上げ式 昇降機能付テーブル
VRK-F1690 P.339
抗ウイルス跳ね上げ式 昇降機能付テーブル
VTM-1690 P.340
抗ウイルス跳ね上げ式
VFTR-1590N P.338
抗ウイルス福祉用 テーブル
VRK-F1890 P.339
抗ウイルス跳ね上げ式 昇降機能付テーブル
VRK-F1690 P.339
抗ウイルス跳ね上げ式 昇降機能付テーブル
VTM-1690 P.340
抗ウイルス跳ね上げ式

































































































































































 ASO-CF750B(SGR)
ASO-WC2F-NA(GJ)
ASO-CTB(LGN)
ASO-WH1811B(MAK)
ASO-CTB(BL)
ASO-CF750B(SGR)
ASO-WC2F-NA(GJ)
ASO-CTB(LGN)
ASO-WH1811B(MAK)
ASO-CTB(BL)




 ASO-CF750W(NA)
ASO-L01B(PK)
ASO-WC1(IV)
ASO-CF750W(NA)
ASO-L01B(PK)
ASO-WC1(IV)

 ASO-HCT1845B(NA)
ALES-CTB(NA)
ASO-CF7575B(NA)
ASO-PT1211RH(NA)
ASO-WC1(BL)
ASO-HCT1845B(NA)
ASO-S9045B(NA)
ALES-CTB(NA)
ASO-HCT1845B(NA)
ALES-CTB(NA)
ASO-CF7575B(NA)
ASO-PT1211RH(NA)
ASO-WC1(BL)
ASO-HCT1845B(NA)
ASO-S9045B(NA)
ALES-CTB(NA)




 ASO-CF750B(NA)
ASO-CT1845B(NA)
ASO-WC2F-NA(MS)
ASO-M1575W(MAK)
ASO-WC2T(NA)
ASO-CF750B(NA)
ASO-CT1845B(NA)
ASO-WC2F-NA(MS)
ASO-M1575W(MAK)
ASO-WC2T(NA)

 ASO-W2411B(MAK)
ASO-OC1(BL)
ASO-LS600N(LGN)
PRO-4W(NA)
ASO-WC2T(NA)
ASO-W2411W(NA)
ASO-S9060B(MAK)
ASO-W2411B(MAK)
ASO-OC1(BL)
ASO-LS600N(LGN)
PRO-4W(NA)
ASO-WC2T(NA)
ASO-W2411W(NA)
ASO-S9060B(MAK)


 ASO-CF1260W(BR)
ASO-LS600S(PK)
ASO-CF6060W(NA)
ASO-SP1B(NV)×2
ASO-SP3B(GR)×1
ASO-LS600S(BJ)
ASO-OC1(GR)
ASO-CF1260W(BR)
ASO-LS600S(PK)
ASO-CF6060W(NA)
ASO-SP1B(NV)×2
ASO-SP3B(GR)×1
ASO-LS600S(BJ)
ASO-OC1(GR)


 ASO-HCT1845B(MAK)
ASO-W2411B(MAK)
CKH11(BK)+CKH11-AR
PRO-4W(NA)
ASO-WC2T(NA)
ASO-W2411W(NA)
ALES-CT(NA)
ASO-L01W(PK) ASO-L02TW(PK) ASO-WH1811W(MAK)
ASO-HCT1845B(MAK)
ASO-W2411B(MAK)
CKH11(BK)+CKH11-AR
PRO-4W(NA)
ASO-WC2T(NA)
ASO-W2411W(NA)
ALES-CT(NA)
ASO-L01W(PK) ASO-L02TW(PK) ASO-WH1811W(MAK)



 ASO-OC1(GR)
ASO-WT6050B(MAK)
ASO-SP1B(GR)×2
ASO-OC1(GR)
ASO-ST400B(MAK)
ASO-SP3W(GR)
ASO-SP1W(GR)
ASO-SP3B(GR)×1
ASO-SP1B(NV)×2
ASO-LS600S(LGN)
ASO-LS600S(BJ)
ASO-SP3W(NV)
ASO-SP3W(GR)
ASO-OC1(GR)
ASO-WT6050B(MAK)
ASO-SP1B(GR)×2
ASO-OC1(GR)
ASO-ST400B(MAK)
ASO-SP3W(GR)
ASO-SP1W(GR)
ASO-SP3B(GR)×1
ASO-SP1B(NV)×2
ASO-LS600S(LGN)
ASO-LS600S(BJ)
ASO-SP3W(NV)
ASO-SP3W(GR)

 ASO-OC1(BL)
ASO-OC1(GN)
ASO-M1575W(MAK)
PHN-1200
ASO-OC1(BL)
ASO-OC1(GN)
ASO-M1575W(MAK)
PHN-1200


 G-TP2+G-TP1
ASO-CF750B(NA)
ASO-WC2F-NA(GJ)
ASO-CF1260W(MAK)
ASO-WC1(BL)
G-TP2+G-TP1
ASO-CF750B(NA)
ASO-WC2F-NA(GJ)
ASO-CF1260W(MAK)
ASO-WC1(BL)


 ASO-S9045B(BR)
ALES-HP-FMS-B
ASO-HC320C(WN)
ASO-HC320C(GR)
ASO-M1890B(BR)
ASO-OC1(GN)
ASO-M1575B(BR)
ASO-S9045B(BR)
ALES-HP-FMS-B
ASO-HC320C(WN)
ASO-HC320C(GR)
ASO-M1890B(BR)
ASO-OC1(GN)
ASO-M1575B(BR)




 ASO-LS600N(LGN)
ASO-CF750W(MAK)
ASO-LS600N(LGN)
ASO-CF750W(MAK)


 ASO-CF 6060W (WH)
ASO-CF1040W(NA)
ASO-LS600N(BL)
ASO-CF1260W(NA)
ASO-CF 6060W (WH)
ASO-CF1040W(NA)
ASO-LS600N(BL)
ASO-CF1260W(NA)


 ASO-L02W(PK)
ASO-CF1260B(BR)
ASO-L01B(LGN)
ASO-L02B(PK)
ASO-L02W(PK)
ASO-CF1260B(BR)
ASO-L01B(LGN)
ASO-L02B(PK)




 ASO-CF6060W(MAK)
ASO-L01W(BR)
ASO-CF1040B(MAK)
ASO-L02B(BL)
ASO-L01W(LGN)
ASO-L02TW(BR)
ASO-CF1260W(BR)
ASO-L01B(BR)
ASO-L02TB(BR)
G-TP2+G-TP1
ASO-PB1530L(NA)
ASO-BLS(LGR)
ASO-CF6060W(MAK)
ASO-L01W(BR)
ASO-CF1040B(MAK)
ASO-L02B(BL)
ASO-L01W(LGN)
ASO-L02TW(BR)
ASO-CF1260W(BR)
ASO-L01B(BR)
ASO-L02TB(BR)
G-TP2+G-TP1
ASO-PB1530L(NA)
ASO-BLS(LGR)




























































































































































































































 ASO-BLS(LGR)
CK03(GN)
ASO-BLS(IV)
ASO-ST400R(SGR)
ASO-PB1530H(NA)
ASO-PB1530L(NA)
ASO-OT1260(MAK)
ASO-BLS(LGR)
CK03(GN)
ASO-BLS(IV)
ASO-ST400R(SGR)
ASO-PB1530H(NA)
ASO-PB1530L(NA)
ASO-OT1260(MAK)





































































































































































 テーブル NOTK-2412(NA) P.207
SOCIA G-YK16 P.070
SOCIA ASO-S9060B(MAK) P.065
テーブル NOTK-2412(NA) P.207
SOCIA G-YK16 P.070
SOCIA ASO-S9060B(MAK) P.065












 デスク FDC-2412B P.204
テーブル ACS-900 P.139
パーティション MP-1809FAR
+MP-F×2
P.156
デスク FDC-2412B P.204
テーブル ACS-900 P.139
パーティション MP-1809FAR
+MP-F×2
P.156




















































































































































































































































































































































































 ALES-NA ナチュラル
ALES-BR ブラウン
ALES-AK-B オーク
ALES-CH-B チェリー
ALES-NA
ALES-NA
ALES-NA ナチュラル
ALES-BR ブラウン
ALES-AK-B オーク
ALES-CH-B チェリー
ALES-NA
ALES-NA




























 ALES-H(NA) ナチュラル
ALES-H(BR) ブラウン
ALES-H-NA-B ナチュラル
ALES-H(NA) ナチュラル
ALES-H(BR) ブラウン
ALES-H-NA-B ナチュラル








































































































































































































































































 LDC-L127B(NA)
G-TN18
LDC-TP1270(BL)
SKC-1(BK)
CK02(OR)
LDC-L127B(NA)
LDC-L127W(WH)
LDC-TP1270(BL)
LDC-L127W(WH)
LDC-L127B(NA)
G-TN18
LDC-TP1270(BL)
SKC-1(BK)
CK02(OR)
LDC-L127B(NA)
LDC-L127W(WH)
LDC-TP1270(BL)
LDC-L127W(WH)























































































































































































































































































































 脇机 LDC-WD3(WH) P.137
チェア CK01(BK) P.079 デスク LDC-H127(WH) P.137
チェア HP-330LG(PK) P.094
AP-1509V(PK)、PSA-FK×2
脇机 LDC-WD3(WH) P.137
チェア CK01(BK) P.079 デスク LDC-H127(WH) P.137
チェア HP-330LG(PK) P.094
AP-1509V(PK)、PSA-FK×2


















 PSB-1512A(PIV)
PSB-1507A(PIV)
ロビー RO-S1200(FBJ) P.256 SOCIA ASO-DT-1290B(MAK) P.044
PSB-1512A(PIV)
PSB-1507A(PIV)
ロビー RO-S1200(FBJ) P.256 SOCIA ASO-DT-1290B(MAK) P.044













































































































































































































 ASO-SP1B/ SP1W
ASO-SP1B/ SP1W









































 TPA-R1809B(LYE)
G-OVT16
SOCIA ASO-WC-2T(NA) P.053
TPA-A1809B(GR)
TPA-R1809B(LYE)TPA-R1509B(LPK)TPA-A1809B(GR)TPA-A1509B(BJ)
TPA-R1809B(LYE)
G-OVT16
SOCIA ASO-WC-2T(NA) P.053
TPA-A1809B(GR)
TPA-R1809B(LYE)TPA-R1509B(LPK)TPA-A1809B(GR)TPA-A1509B(BJ)








 抗ウイルスタイプ
チェア LM1(BL) P.082
TPA-V1809B(BL)
TPA-M1809B(WT)
TPA-V
抗ウイルスタイプ
チェア LM1(BL) P.082
TPA-V1809B(BL)
TPA-M1809B(WT)
TPA-V








































































































































































































































































































































































































































































































 チェア ALES-T-NA P.116
SIK-1875VA(NA)
SIK-1875VM(NA)
MK-480(WH)
SIK-1875VA(NA)
SIK-1875VA(BR)
SIK-1875VM(NA)
SIK-1875VM(WH)
ALES用フック
MK用フック
ALES設置
MK-480設置
対応チェア
ALES-CH-B ALES-H-BR ALES-T-NA-B
チェア ALES-T-NA P.116
SIK-1875VA(NA)
SIK-1875VM(NA)
MK-480(WH)
SIK-1875VA(NA)
SIK-1875VA(BR)
SIK-1875VM(NA)
SIK-1875VM(WH)
ALES用フック
MK用フック
ALES設置
MK-480設置
対応チェア
ALES-CH-B ALES-H-BR ALES-T-NA-B












































































































































































































































































































































































































































































































































































































































































































 KBM-301
KBM-401L
KBS-203 + KBM-301(×2)
KBS-203C + KBM-301(×2)
KBS-203R 1段ベッドとしても使用できます。
KBM-302L
マットレスは別売りとなります。
KBM-301
KBM-401L
KBS-203 + KBM-301(×2)
KBS-203C + KBM-301(×2)
KBS-203R 1段ベッドとしても使用できます。
KBM-302L
マットレスは別売りとなります。
















































































































 プレス機 最大8tの圧で部材加工が可能なプレスマシン。
プレス機 最大8tの圧で部材加工が可能なプレスマシン。
















 鹿児島実業高等学校
某公共施設
長崎市役所 新庁舎
長崎市役所 新庁舎
美容室・サロンの受付カウンター
鹿児島実業高等学校
某公共施設
長崎市役所 新庁舎
長崎市役所 新庁舎
美容室・サロンの受付カウンター















































 ASO-ST400R(NA)
ASO-ST400R(NA)





 アクセサリー AS-PF20(BK) P.284 VKD-1250H(NA)
VKDK-1250(NA)
VKD-9050L(NA)
VKD-9050L(NA)
VKDK-1250(NA)
アクセサリー AS-PF20(BK) P.284 VKD-1250H(NA)
VKDK-1250(NA)
VKD-9050L(NA)
VKD-9050L(NA)
VKDK-1250(NA)













 VHCT-845(NA)
VHCT-C500(NA) VHCT-1245(NA)
VLCT-870(NA)
チェア
CK01(BK) P.079
VLCT-C800(NA)
VLCT-1570(NA)
VLCT-KP870(NA)
VHCT-1545(NA)
VKDK-1250
VKD-9050L
VHCT-845(NA)
VHCT-C500(NA) VHCT-1245(NA)
VLCT-870(NA)
チェア
CK01(BK) P.079
VLCT-C800(NA)
VLCT-1570(NA)
VLCT-KP870(NA)
VHCT-1545(NA)
VKDK-1250
VKD-9050L












 VLCT-870(NA)
VLCT-C800(NA)
VLCT-1570(NA)
VLCT-KP870(NA)
VLCT-870(NA)
VLCT-C800(NA)
VLCT-1570(NA)
VLCT-KP870(NA)
VHCT-1545(NA)
VHCT-845(NA)
VHCT-C500(NA)
VHCT-1245(NA)
VLCT-870(NA)
VLCT-C800(NA)
VLCT-1570(NA)
VLCT-KP870(NA)
VLCT-870(NA)
VLCT-C800(NA)
VLCT-1570(NA)
VLCT-KP870(NA)
VHCT-1545(NA)
VHCT-845(NA)
VHCT-C500(NA)
VHCT-1245(NA)



























































































































































































































































































































































































































































































































































































































































 UC-900(BK)
UC-900(WH)
UC-900(WH) 中棚付
SCT-6545(BK)
UC-900(BK)
UC-900(WH)
UC-900(WH) 中棚付
SCT-6545(BK)






































































































































































 ABP-BK
ABP-BK

















